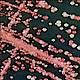
Fig.9 taken from Malinovska et al, 2012.
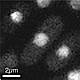
Fig.1 taken from Guarino et al, 2014.
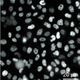

|
Kuerschner L, Moessinger C, Thiele C
|
Imaging of lipid biosynthesis: how a neutral lipid enters lipid droplets.
|
Traffic 2008 Mar 11;9(3):338-52
|
|
Cell Biology
|

|
18088320 |
|
The biosynthesis and storage of triglyceride (TG) is an important cellular process conserved from yeast to man. Most mammalian cells accumulate TG in lipid droplets, most prominent in adipocytes, which are specialized to store large amounts of the TG over long periods. In this study, we followed TG biosynthesis and targeting by fluorescence imaging in living 3T3-L1 adipocytes and COS7 fibroblasts. Key findings were (i) not only TG but also its direct metabolic precursor diacylglycerol, DG, accumulates on lipid droplets; (ii) the essential enzyme diacylglycerol acyltransferase 2 associates specifically with lipid droplets where it catalyzes the conversion of DG to TG and (iii) individual lipid droplets within one cell acquire TG at very different rates, suggesting unequal access to the biosynthetic machinery. We conclude that at least part of TG biosynthesis takes place in the immediate vicinity of lipid droplets. In vitro assays on purified lipid droplets show that this fraction of the biosynthetic TG is directly inserted into the growing droplet. |
|
Bauer N, Fonseca AV, Florek M, Freund D, Jászai J, Bornhäuser M, Fargeas CA, Corbeil D
|
New insights into the cell biology of hematopoietic progenitors by studying prominin-1 (CD133).
|
Cells Tissues Organs (Print) 2008 Dec 21;188(1-2):127-38
|
|
Medical Biology
|
|
18160824 |
|
Prominin-1 (alias CD133) has received considerable interest because of its expression by several stem and progenitor cells originating from various sources, including the neural and hematopoietic systems. As a cell surface marker, prominin-1 is now used for somatic stem cell isolation. Its expression in cancer stem cells has broadened its clinical value, as it might be useful to outline new prospects for more effective cancer therapies by targeting tumor-initiating cells. Cell biological studies of this molecule have demonstrated that it is specifically concentrated in various membrane structures that protrude from the planar areas of the plasmalemma. Prominin-1 binds to the plasma membrane cholesterol and is associated with a particular membrane microdomain in a cholesterol-dependent manner. Although its physiological function is not yet determined, it is becoming clear that this cell surface protein, as a unique marker of both plasma membrane protrusions and membrane microdomains, might reveal new aspects of the cell biology of rare stem and cancer stem cells. The aim of this review is to outline the recent discoveries regarding the dynamic reorganization of the plasma membrane of rare CD133+ hematopoietic progenitor cells during cell migration and division. |
|
Mziaut H, Kersting S, Knoch KP, Fan WH, Trajkovski M, Erdmann K, Bergert H, Ehehalt F, Saeger HD, Solimena M
|
ICA512 signaling enhances pancreatic beta-cell proliferation by regulating cyclins D through STATs.
|
Proc. Natl. Acad. Sci. U.S.A. 2008 Jan 15;105(2):674-9
|
|
Medical Biology
|

|
18178618 |
|
Changes in metabolic demands dynamically regulate the total mass of adult pancreatic beta-cells to adjust insulin secretion and preserve glucose homeostasis. Glucose itself is a major regulator of beta-cell proliferation by inducing insulin secretion and activating beta-cell insulin receptors. Here, we show that islet cell autoantigen 512 (ICA512)/IA-2, an intrinsic tyrosine phosphatase-like protein of the secretory granules, activates a complementary pathway for beta-cell proliferation. On granule exocytosis, the ICA512 cytoplasmic domain is cleaved and the resulting cytosolic fragment (ICA512-CCF) moves into the nucleus where it enhances the levels of phosphorylated STAT5 and STAT3, thereby inducing insulin gene transcription and granule biogenesis. We now show that knockdown of ICA512 decreases cyclin D1 levels and proliferation of insulinoma INS-1 cells, whereas beta-cell regeneration is reduced in partially pancreatectomized ICA512-/- mice. Conversely, overexpression of ICA512-CCF increases both cyclin D1 and D2 levels and INS-1 cell proliferation. Up-regulation of cyclin D1 and D2 by ICA512-CCF is affected by knockdown of STAT3 and STAT5, respectively, whereas it does not require insulin signaling. These results identify ICA512 as a regulator of cyclins D and beta-cell proliferation through STATs and may have implication for diabetes therapy. |
|
Brouhard GJ, Stear JH, Noetzel TL, Al-Bassam J, Kinoshita K, Harrison SC, Howard J, Hyman AA
|
XMAP215 is a processive microtubule polymerase.
|
Cell 2008 Jan 11;132(1):79-88
|
|
Cell Biology
|

|
18191222 |
|
Fast growth of microtubules is essential for rapid assembly of the microtubule cytoskeleton during cell proliferation and differentiation. XMAP215 belongs to a conserved family of proteins that promote microtubule growth. To determine how XMAP215 accelerates growth, we developed a single-molecule assay to visualize directly XMAP215-GFP interacting with dynamic microtubules. XMAP215 binds free tubulin in a 1:1 complex that interacts with the microtubule lattice and targets the ends by a diffusion-facilitated mechanism. XMAP215 persists at the plus end for many rounds of tubulin subunit addition in a form of "tip tracking." These results show that XMAP215 is a processive polymerase that directly catalyzes the addition of up to 25 tubulin dimers to the growing plus end. Under some circumstances XMAP215 can also catalyze the reverse reaction, namely microtubule shrinkage. The similarities between XMAP215 and formins, actin polymerases, suggest that processive tip tracking is a common mechanism for stimulating the growth of cytoskeletal polymers. |
|
Valtink M, Gruschwitz R, Funk RH, Engelmann K
|
Two clonal cell lines of immortalized human corneal endothelial cells show either differentiated or precursor cell characteristics.
|
Cells Tissues Organs (Print) 2008 Jan 14;187(4):286-94
|
|
Medical Biology
|
|
18196893 |
|
Access to primary human corneal endothelial cells (HCEC) is limited and donor-derived differences between cultures exacerbate the issue of data reproducibility, whereas cell lines can provide sufficient numbers of homogenous cells for multiple experiments. An immortalized HCEC population was adapted to serum-free culture medium and repeated cloning was performed. Clonally grown cells were propagated under serum-free conditions and growth curves were recorded. Cells were characterized immunocytochemically for junctional proteins, collagens, Na,K-ATPase and HCEC-specific 9.3.E-antigen. Ultrastructure was monitored by scanning and transmission electron microscopy. Two clonal cell lines, HCEC-B4G12 and HCEC-H9C1, could be isolated and expanded, which differed morphologically: B4G12 cells were polygonal, strongly adherent and formed a strict monolayer, H9C1 cells were less adherent and formed floating spheres. The generation time of B4G12 cells was 62.26 +/- 14.5 h and that of H9C1 cells 44.05 +/- 5.05 h. Scanning electron microscopy revealed that B4G12 cells had a smooth cell surface, while H9C1 cells had numerous thin filopodia. Both cell lines expressed ZO-1 and occludin adequately, and little but well detectable amounts of connexin-43. Expression of HCEC-specific 9.3.E-antigen was found commensurately in both cell lines, while expression of Na,K-ATPase alpha1 was higher in H9C1 cells than in B4G12 cells. B4G12 cells expressed collagen IV abundantly and almost no collagen III, while H9C1 cells expressed both collagens at reasonable amounts. It is concluded that the clonal cell line B4G12 represents an ideal model of differentiated HCEC, while H9C1 may reflect features of developing or transitional HCEC. |
|
Zhu F, Lawo S, Bird A, Pinchev D, Ralph A, Richter C, Müller-Reichert T, Kittler R, Hyman AA, Pelletier L
|
The mammalian SPD-2 ortholog Cep192 regulates centrosome biogenesis.
|
Curr. Biol. 2008 Jan 22;18(2):136-41
|
|
Cell Biology
|

|
18207742 |
|
Centrosomes are the major microtubule-organizing centers of mammalian cells. They are composed of a centriole pair and surrounding microtubule-nucleating material termed pericentriolar material (PCM). Bipolar mitotic spindle assembly relies on two intertwined processes: centriole duplication and centrosome maturation. In the first process, the single interphase centrosome duplicates in a tightly regulated manner so that two centrosomes are present in mitosis. In the second process, the two centrosomes increase in size and microtubule nucleation capacity through PCM recruitment, a process referred to as centrosome maturation. Failure to properly orchestrate centrosome duplication and maturation is inevitably linked to spindle defects, which can result in aneuploidy and promote cancer progression. It has been proposed that centriole assembly during duplication relies on both PCM and centriole proteins, raising the possibility that centriole duplication depends on PCM recruitment. In support of this model, C. elegans SPD-2 and mammalian NEDD-1 (GCP-WD) are key regulators of both these processes. SPD-2 protein sequence homologs have been identified in flies, mice, and humans, but their roles in centrosome biogenesis until now have remained unclear. Here, we show that Cep192, the human homolog of C. elegans and D. melanogaster SPD-2, is a major regulator of PCM recruitment, centrosome maturation, and centriole duplication in mammalian cells. We propose a model in which Cep192 and Pericentrin are mutually dependent for their localization to mitotic centrosomes during centrosome maturation. Both proteins are then required for NEDD-1 recruitment and the subsequent assembly of gamma-TuRCs and other factors into fully functional centrosomes. |
|
Schröter C, Herrgen L, Cardona A, Brouhard GJ, Feldman B, Oates AC
|
Dynamics of zebrafish somitogenesis.
|
Dev. Dyn. 2008 Mar;237(3):545-53
|
|
Developmental Biology
|
|
18265021 |
|
Vertebrate somitogenesis is a rhythmically repeated morphogenetic process. The dependence of somitogenesis dynamics on axial position and temperature has not been investigated systematically in any species. Here we use multiple embryo time-lapse imaging to precisely estimate somitogenesis period and somite length under various conditions in the zebrafish embryo. Somites form at a constant period along the trunk, but the period gradually increases in the tail. Somite length varies along the axis in a stereotypical manner, with tail somites decreasing in size. Therefore, our measurements prompt important modifications to the steady-state Clock and Wavefront model: somitogenesis period, somite length, and wavefront velocity all change with axial position. Finally, we show that somitogenesis period changes more than threefold across the standard developmental temperature range, whereas the axial somite length distribution is temperature invariant. This finding indicates that the temperature-induced change in somitogenesis period exactly compensates for altered axial growth. |
|
Baust T, Anitei M, Czupalla C, Parshyna I, Bourel L, Thiele C, Krause E, Hoflack B
|
Protein networks supporting AP-3 function in targeting lysosomal membrane proteins.
|
Mol. Biol. Cell 2008 May 20;19(5):1942-51
|
|
Cell Biology
|
|
18287518 |
|
The AP-3 adaptor complex targets selected transmembrane proteins to lysosomes and lysosome-related organelles. We reconstituted its preferred interaction with liposomes containing the ADP ribosylation factor (ARF)-1 guanosine triphosphatase (GTPase), specific cargo tails, and phosphatidylinositol-3 phosphate, and then we performed a proteomic screen to identify new proteins supporting its sorting function. We identified approximately 30 proteins belonging to three networks regulating either AP-3 coat assembly or septin polymerization or Rab7-dependent lysosomal transport. RNA interference shows that, among these proteins, the ARF-1 exchange factor brefeldin A-inhibited exchange factor 1, the ARF-1 GTPase-activating protein 1, the Cdc42-interacting Cdc42 effector protein 4, an effector of septin-polymerizing GTPases, and the phosphatidylinositol-3 kinase IIIC3 are key components regulating the targeting of lysosomal membrane proteins to lysosomes in vivo. This analysis reveals that these proteins, together with AP-3, play an essential role in protein sorting at early endosomes, thereby regulating the integrity of these organelles. |
|
Demmel L, Gravert M, Ercan E, Habermann B, Müller-Reichert T, Kukhtina V, Haucke V, Baust T, Sohrmann M, Kalaidzidis Y, Klose C, Beck M, Peter M, Walch-Solimena C
|
The clathrin adaptor Gga2p is a phosphatidylinositol 4-phosphate effector at the Golgi exit.
|
Mol. Biol. Cell 2008 May 20;19(5):1991-2002
|
|
Cell Biology
|
|
18287542 |
|
Phosphatidylinositol 4-phosphate (PI(4)P) is a key regulator of membrane transport required for the formation of transport carriers from the trans-Golgi network (TGN). The molecular mechanisms of PI(4)P signaling in this process are still poorly understood. In a search for PI(4)P effector molecules, we performed a screen for synthetic lethals in a background of reduced PI(4)P and found the gene GGA2. Our analysis uncovered a PI(4)P-dependent recruitment of the clathrin adaptor Gga2p to the TGN during Golgi-to-endosome trafficking. Gga2p recruitment to liposomes is stimulated both by PI(4)P and the small GTPase Arf1p in its active conformation, implicating these two molecules in the recruitment of Gga2p to the TGN, which ultimately controls the formation of clathrin-coated vesicles. PI(4)P binding occurs through a phosphoinositide-binding signature within the N-terminal VHS domain of Gga2p resembling a motif found in other clathrin interacting proteins. These data provide an explanation for the TGN-specific membrane recruitment of Gga2p. |
|
Bollenbach T, Pantazis P, Kicheva A, Bökel C, González-Gaitán M, Jülicher F
|
Precision of the Dpp gradient.
|
Development 2008 Mar;135(6):1137-46
|
|
Developmental Biology
|

|
18296653 |
|
Morphogen concentration gradients provide positional information by activating target genes in a concentration-dependent manner. Recent reports show that the gradient of the syncytial morphogen Bicoid seems to provide precise positional information to determine target gene domains. For secreted morphogenetic ligands, the precision of the gradients, the signal transduction and the reliability of target gene expression domains have not been studied. Here we investigate these issues for the TGF-beta-type morphogen Dpp. We first studied theoretically how cell-to-cell variability in the source, the target tissue, or both, contribute to the variations of the gradient. Fluctuations in the source and target generate a local maximum of precision at a finite distance to the source. We then determined experimentally in the wing epithelium: (1) the precision of the Dpp concentration gradient; (2) the precision of the Dpp signaling activity profile; and (3) the precision of activation of the Dpp target gene spalt. As captured by our theoretical description, the Dpp gradient provides positional information with a maximal precision a few cells away from the source. This maximal precision corresponds to a positional uncertainly of about a single cell diameter. The precision of the Dpp gradient accounts for the precision of the spalt expression range, implying that Dpp can act as a morphogen to coarsely determine the expression pattern of target genes. |
|
Torkko JM, Manninen A, Schuck S, Simons K
|
Depletion of apical transport proteins perturbs epithelial cyst formation and ciliogenesis.
|
J. Cell. Sci. 2008 Apr 15;121(Pt 8):1193-203
|
|
Cell Biology
|

|
18349078 |
|
Epithelial cells are vital for maintaining the complex architecture and functions of organs in the body. Directed by cues from the extracellular matrix, cells polarize their surface into apical and basolateral domains, and connect by extensive cell-cell junctions to form tightly vowen epithelial layers. In fully polarized cells, primary cilia project from the apical surface. Madin-Darby canine kidney (MDCK) cells provide a model to study organization of cells as monolayers and also in 3D in cysts. In this study retrovirus-mediated RNA interference (RNAi) was used to generate a series of knockdowns (KDs) for proteins implicated in apical transport: annexin-13, caveolin-1, galectin-3, syntaxin-3, syntaxin-2 and VIP17 and/or MAL. Cyst cultures were then employed to study the effects of these KDs on epithelial morphogenesis. Depletion of these proteins by RNAi stalled the development of the apical lumen in cysts and resulted in impaired ciliogenesis. The most severe ciliary defects were observed in annexin-13 and syntaxin-3 KD cysts. Although the phenotypes demonstrate the robustness of the formation of the polarized membrane domains, they indicate the important role of apical membrane biogenesis in epithelial organization. |
|
Stanek D, Pridalová-Hnilicová J, Novotný I, Huranová M, Blazíková M, Wen X, Sapra AK, Neugebauer KM
|
Spliceosomal small nuclear ribonucleoprotein particles repeatedly cycle through Cajal bodies.
|
Mol. Biol. Cell 2008 Jun 26;19(6):2534-43
|
|
Cell Biology
|

|
18367544 |
|
The Cajal body (CB) is a nuclear structure closely associated with import and biogenesis of small nuclear ribonucleoprotein particles (snRNPs). Here, we tested whether CBs also contain mature snRNPs and whether CB integrity depends on the ongoing snRNP splicing cycle. Sm proteins tagged with photoactivatable and color-maturing variants of fluorescent proteins were used to monitor snRNP behavior in living cells over time; mature snRNPs accumulated in CBs, traveled from one CB to another, and they were not preferentially replaced by newly imported snRNPs. To test whether CB integrity depends on the snRNP splicing cycle, two human orthologues of yeast proteins involved in distinct steps in spliceosome disassembly after splicing, hPrp22 and hNtr1, were depleted by small interfering RNA treatment. Surprisingly, depletion of either protein led to the accumulation of U4/U6 snRNPs in CBs, suggesting that reassembly of the U4/U6.U5 tri-snRNP was delayed. Accordingly, a relative decrease in U5 snRNPs compared with U4/U6 snRNPs was observed in CBs, as well as in nuclear extracts of treated cells. Together, the data show that particular phases of the spliceosome cycle are compartmentalized in living cells, with reassembly of the tri-snRNP occurring in CBs. |
|
Entchev EV, Schwudke D, Zagoriy V, Matyash V, Bogdanova A, Habermann B, Zhu L, Shevchenko A, Kurzchalia TV
|
LET-767 is required for the production of branched chain and long chain fatty acids in Caenorhabditis elegans.
|
J. Biol. Chem. 2008 Jun 20;283(25):17550-60
|
|
Developmental Biology
|

|
18390550 |
|
LET-767 from Caenorhabditis elegans belongs to a family of short chain dehydrogenases/reductases and is homologous to 17beta-hydroxysterol dehydrogenases of type 3 and 3-ketoacyl-CoA reductases. Worms subjected to RNA interference (RNAi) of let-767 displayed multiple growth and developmental defects in the first generation and arrested in the second generation as L1 larvae. To determine the function of LET-767 in vivo, we exploited a biochemical complementation approach, in which let-767 (RNAi)-arrested larvae were rescued by feeding with compounds isolated from wild type worms. The arrest was only rescued by the addition of triacylglycerides extracted from worms but not from various natural sources, such as animal fats and plant oils. The mass spectrometric analyses showed alterations in the fatty acid content of triacylglycerides. Essential for the rescue were odd-numbered fatty acids with monomethyl branched chains. The rescue was improved when worms were additionally supplemented with long chain even-numbered fatty acids. Remarkably, let-767 completely rescued the yeast 3-ketoacyl-CoA reductase mutant (ybr159Delta). Because worm ceramides exclusively contain a monomethyl branched chain sphingoid base, we also investigated ceramides in let-767 (RNAi). Indeed, the amount of ceramides was greatly reduced, and unusual sphingoid bases were observed. Taken together, we conclude that LET-767 is a major 3-ketoacyl-CoA reductase in C. elegans required for the bulk production of monomethyl branched and long chain fatty acids, and the developmental arrest in let-767 (RNAi) worms is caused by the deficiency of the former. |
|
Poser I, Sarov M, Hutchins JR, Hériché JK, Toyoda Y, Pozniakovsky A, Weigl D, Nitzsche A, Hegemann B, Bird AW, Pelletier L, Kittler R, Hua S, Naumann R, Augsburg M, Sykora MM, Hofemeister H, Zhang Y, Nasmyth K, White KP, Dietzel S, Mechtler K, Durbin R, Stewart AF, Peters JM, Buchholz F, Hyman AA
|
BAC TransgeneOmics: a high-throughput method for exploration of protein function in mammals.
|
Nat. Methods 2008 May 06;5(5):409-15
|
|
Imaging Technologies Development
|

|
18391959 |
|
The interpretation of genome sequences requires reliable and standardized methods to assess protein function at high throughput. Here we describe a fast and reliable pipeline to study protein function in mammalian cells based on protein tagging in bacterial artificial chromosomes (BACs). The large size of the BAC transgenes ensures the presence of most, if not all, regulatory elements and results in expression that closely matches that of the endogenous gene. We show that BAC transgenes can be rapidly and reliably generated using 96-well-format recombineering. After stable transfection of these transgenes into human tissue culture cells or mouse embryonic stem cells, the localization, protein-protein and/or protein-DNA interactions of the tagged protein are studied using generic, tag-based assays. The same high-throughput approach will be generally applicable to other model systems. |
|
Richter T, Floetenmeyer M, Ferguson C, Galea J, Goh J, Lindsay MR, Morgan GP, Marsh BJ, Parton RG
|
High-resolution 3D quantitative analysis of caveolar ultrastructure and caveola-cytoskeleton interactions.
|
Traffic 2008 Jun 07;9(6):893-909
|
|
Cell Biology
|

|
18397183 |
|
Caveolae are characteristic invaginations of the mammalian plasma membrane (PM) implicated in lipid regulation, signal transduction and endocytosis. We have employed electron microscope tomography (ET) to quantify caveolae structure-function relationships in three-dimension (3D) at high resolution both in conventionally fixed and in fast-frozen/freeze-substituted (intact) cells as well as immunolabelled PM lawns. Our findings provide a detailed quantitative comparison of the average caveola dimensions for different cell types including tissue endothelial cells and cultured 3T3-L1 adipocytes. These studies revealed the presence of a spiked caveolar coat and a wide caveolar neck open to the extracellular milieu that is sensitive to conventional fixation; the neck region appeared to form a specialized microdomain with associated cytoplasmic material. In endothelial cells in situ in pancreatic islets of Langerhans, the diaphragm spanning the caveolar opening was clearly resolved by ET, and the involuted 3D topology of the cell surface mapped to measure the contribution of caveolar membranes to local increases in the surface area of the PM. The complexity of connections among caveolae and to the actin cytoskeleton and microtubules suggests that individual caveolae may be interconnected through a complex filamentous network to form a single functional unit. |
|
Ozkucur N, Wetzel C, Hollstein F, Richter E, Funk RH, Monsees TK
|
Physical vapor deposition of zirconium or titanium thin films on flexible polyurethane highly support adhesion and physiology of human endothelial cells.
|
J Biomed Mater Res A 2009 Apr;89(1):57-67
|
|
Medical Biology
|

|
18404717 |
|
The aim of this study was to develop and characterize novel metal-polymer constructs to improve the biocompatibility of flexible but hydrophobic polyurethane (PUR) implants. Using a physical vapor deposition (PVD) technique, thin films (< or =100 nm) of zirconium (Zr) or titanium (Ti) were deposited on the polyurethane surface. Both coatings displayed good stability when subjected to cross-cutting test and especially Zr showed only minor and superficial cracks in the scanning electron microscopy analysis. PVD coating resulted in significantly lowered contact angles and the standard surface free energy of wetting (Delta(wet)G degrees ) turned to more favorable negative values (Ti: -40; Zr: -30; untreated PUR (uPUR): +10.1 mN/m). This may lead to the highly enhanced adhesion and proliferation properties observed with human umbilical vein endothelial cells (HUVECs). In addition, the novel coatings had no toxic effect and even drastically reduced apoptosis rates of HUVECs. Cell morphology, nitric oxide production, and mitochondrial membrane potential--both at static and flow conditions--were superior compared with uPUR, thus demonstrating intact physiological functions. Therefore, we suggest that combining PUR as a flexible material with a thin coating of Zr or Ti as the improved biocompatible surface may have advantages for use, for example, vascular graft material. |
|
McDonald K, Müller-Reichert T
|
New developments in high-pressure freezing. Introduction.
|
J Microsc 2008 May;230(Pt 2):252
|
|
Imaging Technologies Development
|
|
18445154 |
|
|
|
Müller-Reichert T, Mäntler J, Srayko M, O'Toole E
|
Electron microscopy of the early Caenorhabditis elegans embryo.
|
J Microsc 2008 May;230(Pt 2):297-307
|
|
Developmental Biology
|

|
18445160 |
|
The early Caenorhabditis elegans embryo is currently a popular model system to study centrosome assembly, kinetochore organization, spindle formation, and cellular polarization. Here, we present and review methods for routine electron microscopy and 3D analysis of the early C. elegans embryo. The first method uses laser-induced chemical fixation to preserve the fine structure of isolated embryos. This approach takes advantage of time-resolved fixation to arrest development at specific stages. The second method uses high-pressure freezing of whole worms followed by freeze-substitution (HPF-FS) for ultrastructural analysis. This technique allows staging of developing early embryos within the worm uterus, and has the advantage of superior sample preservation required for high-resolution 3D reconstruction. The third method uses a correlative approach to stage isolated, single embryos by light microscopy followed by HPF-FS and electron tomography. This procedure combines the advantages of time-resolved fixation and superior ultrastructural preservation by high-pressure freezing and allows a higher throughput electron microscopic analysis. The advantages and disadvantages of these methods for different applications are discussed. |
|
Schenck A, Goto-Silva L, Collinet C, Rhinn M, Giner A, Habermann B, Brand M, Zerial M
|
The endosomal protein Appl1 mediates Akt substrate specificity and cell survival in vertebrate development.
|
Cell 2008 May 2;133(3):486-97
|
|
Developmental Biology
|

|
18455989 |
|
During development of multicellular organisms, cells respond to extracellular cues through nonlinear signal transduction cascades whose principal components have been identified. Nevertheless, the molecular mechanisms underlying specificity of cellular responses remain poorly understood. Spatial distribution of signaling proteins may contribute to signaling specificity. Here, we tested this hypothesis by investigating the role of the Rab5 effector Appl1, an endosomal protein that interacts with transmembrane receptors and Akt. We show that in zebrafish, Appl1 regulates Akt activity and substrate specificity, controlling GSK-3beta but not TSC2. Consistent with this pattern, Appl1 is selectively required for cell survival, most critically in highly expressing tissues. Remarkably, Appl1 function requires its endosomal localization. Indeed, Akt and GSK-3beta, but not TSC2, dynamically associate with Appl1 endosomes upon growth factor stimulation. We propose that partitioning of Akt and selected effectors onto endosomal compartments represents a key mechanism contributing to the specificity of signal transduction in vertebrate development. |
|
Bulgakova NA, Kempkens O, Knust E
|
Multiple domains of Stardust differentially mediate localisation of the Crumbs-Stardust complex during photoreceptor development in Drosophila.
|
J. Cell. Sci. 2008 Jun 15;121(Pt 12)
|
|
Developmental Biology
|

|
18495840 |
|
Drosophila Stardust (Sdt), a member of the MAGUK family of scaffolding proteins, is a constituent of the evolutionarily conserved Crumbs-Stardust (Crb-Sdt) complex that controls epithelial cell polarity in the embryo and morphogenesis of photoreceptor cells. Although apical localisation is a hallmark of the complex in all cell types and in all organisms analysed, only little is known about how individual components are targeted to the apical membrane. We have performed a structure-function analysis of Sdt by constructing transgenic flies that express altered forms of Sdt to determine the roles of individual domains for localisation and function in photoreceptor cells. The results corroborate the observation that the organisation of the Crb-Sdt complex is differentially regulated in pupal and adult photoreceptors. In pupal photoreceptors, only the PDZ domain of Sdt - the binding site of Crb - is required for apical targeting. In adult photoreceptors, by contrast, targeting of Sdt to the stalk membrane, a distinct compartment of the apical membrane between the rhabdomere and the zonula adherens, depends on several domains, and seems to be a two-step process. The N-terminus, including the two ECR domains and a divergent N-terminal L27 domain that binds the multi-PDZ domain protein PATJ in vitro, is necessary for targeting the protein to the apical pole of the cell. The PDZ-, the SH3- and the GUK-domains are required to restrict the protein to the stalk membrane. Drosophila PATJ or Drosophila Lin-7 are stabilised whenever a Sdt variant that contains the respective binding site is present, independently of where the variant is localised. By contrast, only full-length Sdt, confined to the stalk membrane, stabilises and localises Crb, although only in reduced amounts. The amount of Crumbs recruited to the stalk membrane correlates with its length. Our results highlight the importance of the different Sdt domains and point to a more intricate regulation of the Crb-Sdt complex in adult photoreceptor cells. |
|
Jászai J, Fargeas CA, Haase M, Farkas LM, Huttner WB, Corbeil D
|
Robust expression of Prominin-2 all along the adult male reproductive system and urinary bladder.
|
Histochem. Cell Biol. 2008 Oct 07;130(4):749-59
|
|
Cell Biology
|

|
18536929 |
|
Although the male reproductive system seems to be enriched in transcripts encoding for both Prominin genes, little is known about their spatial distribution in distinct segments of this organ system. This is especially true for the less-characterized second Prominin paralogue, Prominin-2. The present study, therefore, mainly examines the expression of Prominin-2 in male mice and reveals the existence of some crucial differences in the tissue compartmentalization of the two Prominin paralogues in the testis, epididymis, seminal vesicle, prostate and urinary bladder. Our in situ hybridization analysis demonstrates that the major domains of overlapping expression between the two Prominin genes are those compartments that are derived ontogenetically from the epigonadal mesonephric tubules, i.e. ductuli efferentes, or from the Wolffian-tube/ductus mesonephricus, for instance the corpus epididymidis and vesicula seminalis. In contrast, the sinus urogenitalis derivative urinary bladder epithelium expresses exclusively Prominin-2, but not Prominin-1 (CD133). The testis expresses only Prominin-1, not Prominin-2. In human prostate, we finally demonstrate that the expression of Prominin-2 (transcript and protein) is highly enriched in cells located in the basal compartment of the glandular epithelium where only a minute population was recently reported to be Prominin-1 positive. Taken together our data indicate that, except for the gonad, Prominin-2 is widely and abundantly expressed along the epithelia of various segments of the adult male genitourinary tract. |
|
Schlichting K, Dahmann C
|
Hedgehog and Dpp signaling induce cadherin Cad86C expression in the morphogenetic furrow during Drosophila eye development.
|
Mech. Dev. 2008 Aug 27;125(8):712-28
|
|
Developmental Biology
|

|
18539010 |
|
During Drosophila eye development, cell differentiation is preceded by the formation of a morphogenetic furrow, which progresses across the epithelium from posterior to anterior. Cells within the morphogenetic furrow are apically constricted and shortened along their apical-basal axis. However, how these cell shape changes and, thus, the progression of the morphogenetic furrow are controlled is not well understood. Here we show that cells simultaneously lacking Hedgehog and Dpp signal transduction fail to shorten and do not enter the morphogenetic furrow. Moreover, we have identified a gene, cadherin Cad86C, which is highly expressed in cells of the leading flank of the morphogenetic furrow. Ectopic activation of either the Hedgehog or Dpp signal transduction pathway results in elevated Cad86C expression. Conversely, simultaneous loss of both Hedgehog and Dpp signal transduction leads to decreased Cad86C expression. Finally, ectopic expression of Cad86C in either eye-antennal imaginal discs or wing imaginal discs results in apical constriction and shortening of cells. We conclude that Hedgehog and Dpp signaling promote the shortening of cells within the morphogenetic furrow. Induction of Cad86C expression might be one mechanism through which Hedgehog and Dpp promote these cell shape changes. |
|
Attardo A, Calegari F, Haubensak W, Wilsch-Bräuninger M, Huttner WB
|
Live imaging at the onset of cortical neurogenesis reveals differential appearance of the neuronal phenotype in apical versus basal progenitor progeny.
|
PLoS ONE 2008 Jun 11;3(6):e2388
|
|
Neurobiology
|

|
18545663 |
|
The neurons of the mammalian brain are generated by progenitors dividing either at the apical surface of the ventricular zone (neuroepithelial and radial glial cells, collectively referred to as apical progenitors) or at its basal side (basal progenitors, also called intermediate progenitors). For apical progenitors, the orientation of the cleavage plane relative to their apical-basal axis is thought to be of critical importance for the fate of the daughter cells. For basal progenitors, the relationship between cell polarity, cleavage plane orientation and the fate of daughter cells is unknown. Here, we have investigated these issues at the very onset of cortical neurogenesis. To directly observe the generation of neurons from apical and basal progenitors, we established a novel transgenic mouse line in which membrane GFP is expressed from the beta-III-tubulin promoter, an early pan-neuronal marker, and crossed this line with a previously described knock-in line in which nuclear GFP is expressed from the Tis21 promoter, a pan-neurogenic progenitor marker. Mitotic Tis21-positive basal progenitors nearly always divided symmetrically, generating two neurons, but, in contrast to symmetrically dividing apical progenitors, lacked apical-basal polarity and showed a nearly randomized cleavage plane orientation. Moreover, the appearance of beta-III-tubulin-driven GFP fluorescence in basal progenitor-derived neurons, in contrast to that in apical progenitor-derived neurons, was so rapid that it suggested the initiation of the neuronal phenotype already in the progenitor. Our observations imply that (i) the loss of apical-basal polarity restricts neuronal progenitors to the symmetric mode of cell division, and that (ii) basal progenitors initiate the expression of neuronal phenotype already before mitosis, in contrast to apical progenitors. |
|
Grimard V, Massier J, Richter D, Schwudke D, Kalaidzidis Y, Fava E, Hermetter A, Thiele C
|
siRNA screening reveals JNK2 as an evolutionary conserved regulator of triglyceride homeostasis.
|
J. Lipid Res. 2008 Nov 08;49(11):2427-40
|
|
Cell Biology
|

|
18612143 |
|
Lipid homeostasis is essential for proper function of cells and organisms. To unravel new regulators of this system, we developed a screening procedure, combining RNA interference in HeLa cells and TLC, which enabled us to monitor modifications of lipid composition resulting from short, interfering RNA knock-downs. We applied this technique to the analysis of 600 human kinases. Despite the occurrence of off-target effects, we identified JNK2 as a new player in triglyceride (TG) homeostasis and lipid droplet metabolism and, more specifically, in the regulation of lipolysis. Similar control of the level of TGs and lipid droplets was observed for its Schizosaccharomyces pombe homolog, Sty1, suggesting an evolutionary conserved function of mitogen-activated protein kinases in the regulation of lipid storage in eukaryotic cells. |
|
Lingwood D, Ries J, Schwille P, Simons K
|
Plasma membranes are poised for activation of raft phase coalescence at physiological temperature.
|
Proc. Natl. Acad. Sci. U.S.A. 2008 Jul 22;105(29):10005-10
|
|
Biophysics
|

|
18621689 |
|
Cell membranes are not randomly organized, but rather are populated by fluctuating nanoassemblies of increased translational order termed lipid rafts. This lateral heterogeneity can be biophysically extended because cooling formaldehyde-isolated plasma membrane preparations results in separation into phases similar to the liquid-ordered (Lo) and liquid-disordered (Ld) states seen in model membrane systems [Baumgart T, et al. (2007) Proc Natl Acad Sci USA 104:3165-3170]. In this work we demonstrate that raft clustering, i.e., amplifying underlying raft-based connectivity to a larger scale, makes an analogous capacity accessible at 37 degrees C. In plasma membranes at this temperature, cholera toxin-mediated cross-linking of the raft ganglioside GM1 induced the sterol-dependent emergence of a slower diffusing micrometer-scale phase that was enriched in cholesterol and selectively reorganized the lateral distribution of membrane proteins. Although parallels can be drawn, we argue that this raft coalescence in a complex biological matrix cannot be explained by only those interactions that define Lo formation in model membranes. Under this light, our induction of raft-phase separation suggests that plasma membrane composition is poised for selective and functional raft clustering at physiologically relevant temperature. |
|
Knels L, Worm M, Wendel M, Roehlecke C, Kniep E, Funk RH
|
Effects of advanced glycation end products-inductor glyoxal and hydrogen peroxide as oxidative stress factors on rat retinal organ cultures and neuroprotection by UK-14,304.
|
J. Neurochem. 2008 Aug 04;106(4):1876-87
|
|
Neurobiology
|

|
18624919 |
|
Retinal ganglion cell degeneration is supposed to be mediated by reactive oxygen species (ROS) and advanced glycation end products (AGEs). The alpha2-adrenergic agonist, 5-bromo-N-(4,5-dihydro-1H-imidazol-2-yl)-6-quinoxalinamine (brimonidine; UK-14,304), is said to exert a neuroprotective effect. To investigate these mechanisms in detail, we exposed rat whole mounts to glyoxal or H(2)O(2) and treated them with either UK-14,304 alone or additionally with the phosphatidylinositide 3 kinase (PI3) kinase inhibitor, 2-(4-Morpholinyl)-8-phenyl-4H-1-benzopyran-4-one (Ly 294002). The accumulation of Nepsilon-[carboxymethyl] lysine (CML) was assessed immunohistochemically and changes in intracellular pH (pHi), mitochondrial transmembrane potential (MTMP) and ROS production in cell bodies of multipolar ganglion cell layer were studied by intravital fluorescence microscopy and confocal laser scanning microscopy. Ultrastructural changes in mitochondria of multipolar ganglion cell layer cell bodies were determined by transmission electron microscopy. We found that glyoxal and H(2)O(2) increased accumulation of CML-modified proteins and ROS production and decreased pHi and MTMP in cell bodies of multipolar ganglion cell layer. UK-14,304 could prevent production of ROS, accumulation of CML-modified proteins, ameliorate acidification, preserve MTMP and attenuate ultrastructural damages of ganglion cell mitochondria. Ly 294002 reversed the UK-14,304-mediated attenuation of CML and ROS production. We conclude that the protective effects of UK-14,304 seem partly to be mediated by PI3 kinase-dependent pathways. |
|
Del Conte-Zerial P, Brusch L, Rink JC, Collinet C, Kalaidzidis Y, Zerial M, Deutsch A
|
Membrane identity and GTPase cascades regulated by toggle and cut-out switches.
|
Mol. Syst. Biol. 2008 Jul 15;4:206
|
|
Cell Biology
|

|
18628746 |
|
Key cellular functions and developmental processes rely on cascades of GTPases. GTPases of the Rab family provide a molecular ID code to the generation, maintenance and transport of intracellular compartments. Here, we addressed the molecular design principles of endocytosis by focusing on the conversion of early endosomes into late endosomes, which entails replacement of Rab5 by Rab7. We modelled this process as a cascade of functional modules of interacting Rab GTPases. We demonstrate that intermodule interactions share similarities with the toggle switch described for the cell cycle. However, Rab5-to-Rab7 conversion is rather based on a newly characterized 'cut-out switch' analogous to an electrical safety-breaker. Both designs require cooperativity of auto-activation loops when coupled to a large pool of cytoplasmic proteins. Live cell imaging and endosome tracking provide experimental support to the cut-out switch in cargo progression and conversion of endosome identity along the degradative pathway. We propose that, by reconciling module performance with progression of activity, the cut-out switch design could underlie the integration of modules in regulatory cascades from a broad range of biological processes. |
|
Schneiders W, Reinstorf A, Biewener A, Serra A, Grass R, Kinscher M, Heineck J, Rehberg S, Zwipp H, Rammelt S
|
In vivo effects of modification of hydroxyapatite/collagen composites with and without chondroitin sulphate on bone remodeling in the sheep tibia.
|
J. Orthop. Res. 2009 Jan;27(1):15-21
|
|
Medical Biology
|

|
18634066 |
|
The addition of chondroitin sulphate (CS) to bone cements with calcium phosphate has lead to an enhancement of bone remodeling and an increase in new bone formation in small animals. The goal of this study was to verify the effect of CS in bone cements in a large animal model simulating a clinically relevant situation of a segmental cortical defect of a critical size on bone-implant interaction and bone remodeling. The influence of adding CS to hydroxyapatite/collagen (HA/Col) composites on host response was assessed in a standard sheep tibia model. A midshaft defect of 3 cm was created in the tibiae of 14 adult female sheep. The defect was filled with a HA/Col cement cylinder in seven animals and with a CS-modified hydroxyapatite/collagen (HA/Col/CS) cement cylinder in seven animals. In all cases the tibia was stabilized with an interlocked universal tibial nail. The animals in each group were analyzed with X-rays, CT scans, histology, immunohistochemistry, and enzymehistochemistry, as well as histomorphometric measurements. The X-ray investigation showed a significantly earlier callus reaction around the HA/Col/CS implants compared to HA/Col alone. The amount of newly formed bone at the end point of the experiment was significantly larger around HA/Col/CS cylinders both in the CT scan and in the histomorphometric analysis. There were still TRAP-positive osteoclasts around the HA/Col implants after 3 months. The number of osteopontin-positive osteoblasts and the direct bone contact were significantly higher around HA/Col/CS implants. We conclude that addition of CS enhances bone remodeling and new bone formation around HA/Col composites. |
|
Oteíza P, Köppen M, Concha ML, Heisenberg CP
|
Origin and shaping of the laterality organ in zebrafish.
|
Development 2008 Aug 17;135(16):2807-13
|
|
Developmental Biology
|

|
18635607 |
|
Handedness of the vertebrate body plan critically depends on transient embryonic structures/organs that generate cilia-dependent leftward fluid flow within constrained extracellular environments. Although the function of ciliated organs in laterality determination has been extensively studied, how they are formed during embryogenesis is still poorly understood. Here we show that Kupffer's vesicle (KV), the zebrafish organ of laterality, arises from a surface epithelium previously thought to adopt exclusively extra-embryonic fates. Live multi-photon confocal imaging reveals that surface epithelial cells undergo Nodal/TGFbeta signalling-dependent ingression at the dorsal germ ring margin prior to gastrulation, to give rise to dorsal forerunner cells (DFCs), the precursors of KV. DFCs then migrate attached to the overlying surface epithelium and rearrange into rosette-like epithelial structures at the end of gastrulation. During early somitogenesis, these epithelial rosettes coalesce into a single rosette that differentiates into the KV with a ciliated lumen at its apical centre. Our results provide novel insights into the morphogenetic transformations that shape the laterality organ in zebrafish and suggest a conserved progenitor role of the surface epithelium during laterality organ formation in vertebrates. |
|
Karbanová J, Missol-Kolka E, Fonseca AV, Lorra C, Janich P, Hollerová H, Jászai J, Ehrmann J, Kolár Z, Liebers C, Arl S, Subrtová D, Freund D, Mokry J, Huttner WB, Corbeil D
|
The stem cell marker CD133 (Prominin-1) is expressed in various human glandular epithelia.
|
J. Histochem. Cytochem. 2008 Nov 21;56(11):977-93
|
|
Medical Biology
|

|
18645205 |
|
Human prominin-1 (CD133) is expressed by various stem and progenitor cells originating from diverse sources. In addition to stem cells, its mouse ortholog is expressed in a broad range of adult epithelial cells, where it is selectively concentrated in their apical domain. The lack of detection of prominin-1 in adult human epithelia might be explained, at least in part, by the specificity of the widely used AC133 antibody, which recognizes an epitope that seems dependent on glycosylation. Here we decided to re-examine its expression in adult human tissues, particularly in glandular epithelia, using a novel monoclonal antibody (80B258) generated against the human prominin-1 polypeptide. In examined tissues, we observed 80B258 immunoreactivity at the apical or apicolateral membranes of polarized cells. For instance, we found expression in secretory serous and mucous cells as well as intercalated ducts of the large salivary and lacrimal glands. In sweat glands including the gland of Moll, 80B258 immunoreactivity was found in the secretory (eccrine and apocrine glands) and duct (eccrine glands) portion. In the liver, 80B258 immunoreactivity was identified in the canals of Hering, bile ductules, and small interlobular bile ducts. In the uterus, we detected 80B258 immunoreactivity in endometrial and cervical glands. Together these data show that the overall expression of human prominin-1 is beyond the rare primitive cells, and it seems to be a general marker of apical or apicolateral membrane of glandular epithelia. This manuscript contains online supplemental material at http://www.jhc.org. Please visit this article online to view these materials. |
|
Bird AW, Hyman AA
|
Building a spindle of the correct length in human cells requires the interaction between TPX2 and Aurora A.
|
J. Cell Biol. 2008 Jul 28;182(2):289-300
|
|
Cell Biology
|

|
18663142 |
|
To assemble mitotic spindles, cells nucleate microtubules from a variety of sources including chromosomes and centrosomes. We know little about how the regulation of microtubule nucleation contributes to spindle bipolarity and spindle size. The Aurora A kinase activator TPX2 is required for microtubule nucleation from chromosomes as well as for spindle bipolarity. We use bacterial artificial chromosome-based recombineering to introduce point mutants that block the interaction between TPX2 and Aurora A into human cells. TPX2 mutants have very short spindles but, surprisingly, are still bipolar and segregate chromosomes. Examination of microtubule nucleation during spindle assembly shows that microtubules fail to nucleate from chromosomes. Thus, chromosome nucleation is not essential for bipolarity during human cell mitosis when centrosomes are present. Rather, chromosome nucleation is involved in spindle pole separation and setting spindle length. A second Aurora A-independent function of TPX2 is required to bipolarize spindles. |
|
Krüger N, Tolic-Nørrelykke IM
|
Association of mitochondria with spindle poles facilitates spindle alignment.
|
Curr. Biol. 2008 Aug 5;18(15):R646-R647
|
|
Cell Biology
|

|
18682200 |
|
|
|
Fish JL, Dehay C, Kennedy H, Huttner WB
|
Making bigger brains-the evolution of neural-progenitor-cell division.
|
J. Cell. Sci. 2008 Sep 1;121(Pt 17):2783-93
|
|
Neurobiology
|

|
18716282 |
|
Relative brain size differs markedly between species. This variation might ultimately result from differences in the cell biology of neural progenitors, which might underlie their different proliferative potential. On the basis of the cell-biological properties of neural progenitors of animals of varying brain size and complexity (namely, Drosophila melanogaster, rodents and primates), we hypothesize that the evolution of four related cell-biological features has contributed to increases in neuron number. Three of these features-the pseudostratification of the progenitor layer, the loss of (Inscuteable-mediated) mitotic-spindle rotation and the evolution of proteins (such as Aspm) that maintain the precision of symmetric progenitor division-affect the mode of cell division in the apically dividing progenitors of the ventricular zone. The fourth feature, however, concerns the evolution of the basally dividing progenitors of the subventricular zone. In rodents, these basal (or intermediate) progenitors lack cell polarity, whereas in primates a subpopulation of radial, presumably polarized, progenitors has evolved (outer-subventricular-zone progenitors). These cells undergo basal mitoses and are thought to retain epithelial characteristics. We propose the epithelial-progenitor hypothesis, which argues that evolutionary changes that promote the maintenance of epithelial features in neural progenitors, including outer-subventricular-zone progenitors, have been instrumental in the expansion of the cerebral cortex in primates. |
|
Ocana-Morgner C, Wahren C, Jessberger R
|
SWAP-70 regulates RhoA/RhoB-dependent MHCII surface localization in dendritic cells.
|
Blood 2009 Feb 12;113(7):1474-82
|
|
Cell Biology
|

|
18802007 |
|
Stimulated dendritic cells (DCs) mature and migrate to lymphoid organs to prime naive T cells. DC maturation augments antigen-presentation capacity of DCs by increasing peptide loading, half-life, and cell surface localization of MHC molecules. Activated SWAP-70(-/-) DCs fail to properly localize MHCII molecules in the plasma membrane, are strongly impaired in T-cell activation, and are altered in F-actin rearrangement. MHCII synthesis, invariant chain removal, and MHCII internalization, however, are unaffected. MHCII surface localization is known to require RhoGTPases. Surprisingly, SWAP70, hitherto known to bind F-actin and Rac, also binds RhoA-GTP. In SWAP-70(-/-) DCs, RhoA and RhoB are stimulus-independent and constitutively active. Surface localization of MHCII molecules and T-cell activation can be restored by blocking RhoA and RhoB before but not during DC activation. Thus, contrasting positive regulation of Rac, SWAP-70 negatively regulates RhoA and-indirectly-RhoB, preventing premature RhoA/RhoB activation. Through RhoA/RhoB regulation, SWAP-70 defines a new pathway to control surface localization of MHCII, a critical element in DC-dependent immune responses. |
|
Trajkovski M, Mziaut H, Schubert S, Kalaidzidis Y, Altkrüger A, Solimena M
|
Regulation of insulin granule turnover in pancreatic beta-cells by cleaved ICA512.
|
J. Biol. Chem. 2008 Nov 28;283(48):33719-29
|
|
Medical Biology
|

|
18824546 |
|
Insulin maintains homeostasis of glucose by promoting its uptake into cells from the blood. Hyperglycemia triggers secretion of insulin from pancreatic beta-cells. This process is mediated by secretory granule exocytosis. However, how beta-cells keep granule stores relatively constant is still unknown. ICA512 is an intrinsic granule membrane protein, whose cytosolic domain binds beta2-syntrophin, an F-actin-associated protein, and is cleaved upon granule exocytosis. The resulting cleaved cytosolic fragment, ICA512-CCF, reaches the nucleus and up-regulates the transcription of granule genes, including insulin and ICA512. Here, we show that ICA512-CCF also dimerizes with intact ICA512 on granules, thereby displacing it from beta2-syntrophin. This leads to increased granule mobility and insulin release. Based on these findings, we propose a model whereby the generation of ICA512-CCF first amplifies insulin secretion. The ensuing reduction of granule stores would then increase the probability of newly generated ICA512-CCF to reach the nucleus and enhance granule biogenesis, thus allowing beta-cells to constantly adjust production of granules to their storage size and consumption. Pharmacological modulation of these feedback loops may alleviate deficient insulin release in diabetes. |
|
Farkas LM, Haffner C, Giger T, Khaitovich P, Nowick K, Birchmeier C, Pääbo S, Huttner WB
|
Insulinoma-associated 1 has a panneurogenic role and promotes the generation and expansion of basal progenitors in the developing mouse neocortex.
|
Neuron 2008 Oct 9;60(1):40-55
|
|
Neurobiology
|

|
18940587 |
|
Basal (intermediate) progenitors are the major source of neurons in the mammalian neocortex. The molecular machinery governing basal progenitor biogenesis is unknown. Here, we show that the zinc-finger transcription factor Insm1 (insulinoma-associated 1) is expressed specifically in progenitors undergoing neurogenic divisions, has a panneurogenic role throughout the brain, and promotes basal progenitor formation in the neocortex. Mouse embryos lacking Insm1 contained half the number of basal progenitors and showed a marked reduction in cortical plate radial thickness. Forced premature expression of Insm1 in neuroepithelial cells resulted in their mitosis occurring at the basal (rather than apical) side of the ventricular zone and induced expression of the basal progenitor marker Tbr2. Remarkably, these cells remained negative for Tis21, a marker of neurogenic progenitors, and did not generate neurons but underwent self-amplification. Our data imply that Insm1 is involved in the generation and expansion of basal progenitors, a hallmark of neocortex evolution. |
|
Kosodo Y, Toida K, Dubreuil V, Alexandre P, Schenk J, Kiyokage E, Attardo A, Mora-Bermúdez F, Arii T, Clarke JD, Huttner WB
|
Cytokinesis of neuroepithelial cells can divide their basal process before anaphase.
|
EMBO J. 2008 Dec 3;27(23):3151-63
|
|
Cell Biology
|

|
18971946 |
|
Neuroepithelial (NE) cells, the primary stem and progenitor cells of the vertebrate central nervous system, are highly polarized and elongated. They retain a basal process extending to the basal lamina, while undergoing mitosis at the apical side of the ventricular zone. By studying NE cells in the embryonic mouse, chick and zebrafish central nervous system using confocal microscopy, electron microscopy and time-lapse imaging, we show here that the basal process of these cells can split during M phase. Splitting occurred in the basal-to-apical direction and was followed by inheritance of the processes by either one or both daughter cells. A cluster of anillin, an essential component of the cytokinesis machinery, appeared at the distal end of the basal process in prophase and was found to colocalize with F-actin at bifurcation sites, in both proliferative and neurogenic NE cells. GFP-anillin in the basal process moved apically to the cell body prior to anaphase onset, followed by basal-to-apical ingression of the cleavage furrow in telophase. The splitting of the basal process of M-phase NE cells has implications for cleavage plane orientation and the relationship between mitosis and cytokinesis. |
|
Bickle M
|
High-content screening: a new primary screening tool?
|
IDrugs 2008 Nov;11(11):822-6
|
|
Imaging Technologies Development
|
|
18988127 |
|
Given a pharmaceutical landscape in which fewer drugs are succeeding in reaching the market, pharmaceutical and biotechnological companies are seeking alternative screening methodologies that will be compatible with the large scale of current combinatorial chemical libraries. In this context, HCS has received considerable attention. Imaging technologies are playing an increasing role in the drug discovery and development process, and this role is projected to increase further in the future. Currently, these technologies are rarely applied in primary screening campaigns but, rather, are used in the processes that precede and follow primary screening. Imaging technologies are employed for target identification and validation, secondary screening, ADMET studies, and pharmacokinetic studies. Various labeling technologies are deployed for such imaging, including fluorescence, luminescence, PET and computer tomography (CT). This feature review discusses high-content analysis (HCA), including the HCS technology and methodology involved, and the future potential of HCA in the drug discovery process. |
|
De Pietri Tonelli D, Pulvers JN, Haffner C, Murchison EP, Hannon GJ, Huttner WB
|
miRNAs are essential for survival and differentiation of newborn neurons but not for expansion of neural progenitors during early neurogenesis in the mouse embryonic neocortex.
|
Development 2008 Dec;135(23):3911-21
|
|
Neurobiology
|

|
18997113 |
|
Neurogenesis during the development of the mammalian cerebral cortex involves a switch of neural stem and progenitor cells from proliferation to differentiation. To explore the possible role of microRNAs (miRNAs) in this process, we conditionally ablated Dicer in the developing mouse neocortex using Emx1-Cre, which is specifically expressed in the dorsal telencephalon as early as embryonic day (E) 9.5. Dicer ablation in neuroepithelial cells, which are the primary neural stem and progenitor cells, and in the neurons derived from them, was evident from E10.5 onwards, as ascertained by the depletion of the normally abundant miRNAs miR-9 and miR-124. Dicer ablation resulted in massive hypotrophy of the postnatal cortex and death of the mice shortly after weaning. Analysis of the cytoarchitecture of the Dicer-ablated cortex revealed a marked reduction in radial thickness starting at E13.5, and defective cortical layering postnatally. Whereas the former was due to neuronal apoptosis starting at E12.5, which was the earliest detectable phenotype, the latter reflected dramatic impairment of neuronal differentiation. Remarkably, the primary target cells of Dicer ablation, the neuroepithelial cells, and the neurogenic progenitors derived from them, were unaffected by miRNA depletion with regard to cell cycle progression, cell division, differentiation and viability during the early stage of neurogenesis, and only underwent apoptosis starting at E14.5. Our results support the emerging concept that progenitors are less dependent on miRNAs than their differentiated progeny, and raise interesting perspectives as to the expansion of somatic stem cells. |
|
Matos J, Lipp JJ, Bogdanova A, Guillot S, Okaz E, Junqueira M, Shevchenko A, Zachariae W
|
Dbf4-dependent CDC7 kinase links DNA replication to the segregation of homologous chromosomes in meiosis I.
|
Cell 2008 Nov 14;135(4):662-78
|
|
Cell Biology
|

|
19013276 |
|
Meiosis differs from mitosis in that DNA replication is followed by the segregation of homologous chromosomes but not sister chromatids. This depends on the formation of interhomolog connections through crossover recombination and on the attachment of sister kinetochores to microtubules emanating from the same spindle pole. We show that in yeast, the Dbf4-dependent Cdc7 kinase (DDK) provides a link between premeiotic S phase, recombination, and monopolar attachment. Independently from its established role in initiating DNA replication, DDK promotes double-strand break formation, the first step of recombination, and the recruitment of the monopolin complex to kinetochores, which is essential for monopolar attachment. DDK regulates monopolin localization together with the polo-kinase Cdc5 bound to Spo13, probably through phosphorylation of the monopolin subunit Lrs4. Thus, activation of DDK both initiates DNA replication and commits meiotic cells to reductional chromosome segregation in the first division of meiosis. |
|
Corbeil D, Joester A, Fargeas CA, Jászai J, Garwood J, Hellwig A, Werner HB, Huttner WB
|
Expression of distinct splice variants of the stem cell marker prominin-1 (CD133) in glial cells.
|
Glia 2009 Jun;57(8):860-74
|
- EMF & Histo CMCB
- LMF CMCB
|
Cell Biology
|

|
19053060 |
|
Prominin-1 (CD133) is a cholesterol-interacting pentaspan membrane glycoprotein specifically associated with plasma membrane protrusions. Prominin-1 is expressed by various stem and progenitor cells, notably neuroepithelial progenitors found in the developing embryonic brain. Here, we further investigated its expression in the murine brain. Biochemical analyses of brain membranes at early stages of development revealed the expression of two distinct splice variants of prominin-1, s1 and s3, which have different cytoplasmic C-terminal domains. The relative abundance of the s3 variant increased toward adulthood, whereas the opposite was observed for the s1 variant. Our combined in situ hybridization and immunohistochemistry revealed the expression of prominin-1 in a subpopulation of Olig-2-positive oligodendroglial cells present within white matter tracts of postnatal and adult brain. Furthermore, immunohistological and biochemical characterization suggested strongly that the s3 variant is a novel component of myelin. Consistent with this, the expression of prominin-1.s3 was significantly reduced in the brain of myelin-deficient mice. Finally, oligodendrocytes expressed selectively the s3 variant whereas GFAP-positive astrocytes expressed the s1 variant in primary glial cell cultures derived from embryonic brains. Collectively, our data demonstrate a complex expression pattern of prominin-1 molecules in developing adult brain. Given that prominin-1 is thought to act as an organizer of plasma membrane protrusions, they further suggest that a specific prominin-1 splice variant might play a role in morphogenesis and/or maintenance of the myelin sheath. |
|
Song MH, Aravind L, Müller-Reichert T, O'Connell KF
|
The conserved protein SZY-20 opposes the Plk4-related kinase ZYG-1 to limit centrosome size.
|
Dev. Cell 2008 Dec;15(6):901-12
|
|
Cell Biology
|

|
19081077 |
|
Microtubules are organized by the centrosome, a dynamic organelle that exhibits changes in both size and number during the cell cycle. Here we show that SZY-20, a putative RNA-binding protein, plays a critical role in limiting centrosome size in C. elegans. SZY-20 localizes in part to centrosomes and in its absence centrosomes possess increased levels of centriolar and pericentriolar components including gamma-tubulin and the centriole duplication factors ZYG-1 and SPD-2. These enlarged centrosomes possess normal centrioles, nucleate more microtubules, and fail to properly direct a number of microtubule-dependent processes. Depletion of ZYG-1 restores normal centrosome size and function to szy-20 mutants, whereas loss of szy-20 suppresses the centrosome duplication defects in both zyg-1 and spd-2 mutants. Our results describe a pathway that determines centrosome size and implicate centriole duplication factors in this process. |
|
Kucera T1, Strilić B, Regener K, Schubert M, Laudet V, Lammert E
|
Ancestral vascular lumen formation via basal cell surfaces.
|
PLoS ONE 2009 Jan 06;4(1):e4132
|
|
Developmental Biology
|

|
19125185 |
|
The cardiovascular system of bilaterians developed from a common ancestor. However, no endothelial cells exist in invertebrates demonstrating that primitive cardiovascular tubes do not require this vertebrate-specific cell type in order to form. This raises the question of how cardiovascular tubes form in invertebrates? Here we discovered that in the invertebrate cephalochordate amphioxus, the basement membranes of endoderm and mesoderm line the lumen of the major vessels, namely aorta and heart. During amphioxus development a laminin-containing extracellular matrix (ECM) was found to fill the space between the basal cell surfaces of endoderm and mesoderm along their anterior-posterior (A-P) axes. Blood cells appear in this ECM-filled tubular space, coincident with the development of a vascular lumen. To get insight into the underlying cellular mechanism, we induced vessels in vitro with a cell polarity similar to the vessels of amphioxus. We show that basal cell surfaces can form a vascular lumen filled with ECM, and that phagocytotic blood cells can clear this luminal ECM to generate a patent vascular lumen. Therefore, our experiments suggest a mechanism of blood vessel formation via basal cell surfaces in amphioxus and possibly in other invertebrates that do not have any endothelial cells. In addition, a comparison between amphioxus and mouse shows that endothelial cells physically separate the basement membranes from the vascular lumen, suggesting that endothelial cells create cardiovascular tubes with a cell polarity of epithelial tubes in vertebrates and mammals. |
|
Heckel T, Czupalla C, Expirto Santo AI, Anitei M, Arantzazu Sanchez-Fernandez M, Mosch K, Krause E, Hoflack B
|
Src-dependent repression of ARF6 is required to maintain podosome-rich sealing zones in bone-digesting osteoclasts.
|
Proc. Natl. Acad. Sci. U.S.A. 2009 Feb 3;106(5):1451-6
|
|
Cell Biology
|

|
19164586 |
|
Bone digestion occurs when osteoclasts adhere onto bone surfaces and polarize to form acidic, hydrolase-rich resorption lacunae. For this process, they condense their actin-rich podosomes in tight belts to establish sealing zones, which segregate their basal membranes from those facing resorption lacunae. This polarization process remains poorly understood. Here, we combined quantitative proteomics and gene silencing to identify new substrates of the Src tyrosine kinase, a key regulator of osteoclast function. We now report that a depletion of the ARF GTPase-activating protein GIT2, which localizes to sealing zones upon Src phosphorylation, or a lack of GTP hydrolysis on ARF6 impairs sealing zone formation and polarized membrane traffic. Surprisingly, the Rho guanine nucleotide exchange factors alpha and beta PIX, which usually coordinate ARF and Rho signaling, were found to be dispensable. We conclude that the Src-dependent localization of GIT2 is essential for down-regulating ARF6 activity at sealing zones, and thus for maintaining osteoclast polarity. |
|
Kowalczyk T, Pontious A, Englund C, Daza RA, Bedogni F, Hodge R, Attardo A, Bell C, Huttner WB, Hevner RF
|
Intermediate neuronal progenitors (basal progenitors) produce pyramidal-projection neurons for all layers of cerebral cortex.
|
Cereb. Cortex 2009 Oct 23;19(10):2439-50
|
|
Neurobiology
|

|
19168665 |
|
The developing cerebral cortex contains apical and basal types of neurogenic progenitor cells. Here, we investigated the cellular properties and neurogenic output of basal progenitors, also called intermediate neuronal progenitors (INPs). We found that basal mitoses expressing transcription factor Tbr2 (an INP marker) were present throughout corticogenesis, from embryonic day 10.5 through birth. Postnatally, Tbr2(+) progenitors were present in the dentate gyrus, subventricular zone (SVZ), and posterior periventricle (pPV). Two morphological subtypes of INPs were distinguished in the embryonic cortex, "short radial" in the ventricular zone (VZ) and multipolar in the SVZ, probably corresponding to molecularly defined INP subtypes. Unexpectedly, many short radial INPs appeared to contact the apical (ventricular) surface and some divided there. Time-lapse video microscopy suggested that apical INP divisions produced daughter INPs. Analysis of neurogenic divisions (Tis21-green fluorescent protein [GFP](+)) indicated that INPs may produce the majority of projection neurons for preplate, deep, and superficial layers. Conversely, proliferative INP divisions (Tis21-GFP(-)) increased from early to middle corticogenesis, concomitant with SVZ growth. Our findings support the hypothesis that regulated amplification of INPs may be an important factor controlling the balance of neurogenesis among different cortical layers. |
|
Rentsch C, Rentsch B, Breier A, Hofmann A, Manthey S, Scharnweber D, Biewener A, Zwipp H
|
Evaluation of the osteogenic potential and vascularization of 3D poly(3)hydroxybutyrate scaffolds subcutaneously implanted in nude rats.
|
J Biomed Mater Res A 2010 Jan;92(1):185-95
|
|
Medical Biology
|

|
19170159 |
|
The aim of this study was to evaluate the osteogenic potential and the vascularization of embroidered, tissue engineered, and cell-seeded 3D poly(3)hydroxybutyrate (PHB) scaffolds in nude rats. Collagen I (coll I)- and collagen I/chondroitin sulfate (coll I/CS)-coated PHB scaffolds were seeded with human mesenchymal stem cells (hMSCs). Proliferation and differentiation were characterized by different biochemical assays in vitro. For animal experiments, the cells were cultivated on coll I- or coll I/CS-coated scaffolds and either expanded or osteogenically differentiated. Scaffolds were piled up to create a 3D scaffold pad and implanted subcutaneously into nude rats. In vitro hMSC showed proliferation and differentiation on PHB scaffolds. Alkaline phosphatase (ALP) and calcium increased in the differentiation medium and in the presence of coll I/CS. In vivo blood vessels were found in the scaffold-stack. Histological/immunohistological analyses of explanted scaffolds showed osteogenic markers such as osteopontin, osteonectin, and coll I around the PHB fibers. Coll I/CS-coated scaffolds with expanded hMSC showed higher values of ALP and calcium than the other combinations. Embroidered PHB scaffolds, coated with extracellular matrix components, provided an adequate environment and, therefore, a template for hMSC which could be differentiated in osteogenic direction. |
|
Zacchigna S, Oh H, Wilsch-Bräuninger M, Missol-Kolka E, Jászai J, Jansen S, Tanimoto N, Tonagel F, Seeliger M, Huttner WB, Corbeil D, Dewerchin M, Vinckier S, Moons L, Carmeliet P
|
Loss of the cholesterol-binding protein prominin-1/CD133 causes disk dysmorphogenesis and photoreceptor degeneration.
|
J. Neurosci. 2009 Feb 18;29(7):2297-308
|
|
Neurobiology
|

|
19228982 |
|
Prominin-1/CD133 (Prom-1) is a commonly used marker of neuronal, vascular, hematopoietic and other stem cells, yet little is known about its biological role and importance in vivo. Here, we show that loss of Prom-1 results in progressive degeneration of mature photoreceptors with complete loss of vision. Despite the expression of Prom-1 on endothelial progenitors, photoreceptor degeneration was not attributable to retinal vessel defects, but caused by intrinsic photoreceptor defects in disk formation, outer segment morphogenesis, and associated with visual pigment sorting and phototransduction abnormalities. These findings shed novel insight on how Prom-1 regulates neural retinal development and phototransduction in vertebrates. |
|
Lingwood D, Schuck S, Ferguson C, Gerl MJ, Simons K
|
Generation of cubic membranes by controlled homotypic interaction of membrane proteins in the endoplasmic reticulum.
|
J. Biol. Chem. 2009 May 1;284(18):12041-8
|
|
Cell Biology
|

|
19258319 |
|
Cell membranes predominantly consist of lamellar lipid bilayers. When studied in vitro, however, many membrane lipids can exhibit non-lamellar morphologies, often with cubic symmetries. An open issue is how lipid polymorphisms influence organelle and cell shape. Here, we used controlled dimerization of artificial membrane proteins in mammalian tissue culture cells to induce an expansion of the endoplasmic reticulum (ER) with cubic symmetry. Although this observation emphasizes ER architectural plasticity, we found that the changed ER membrane became sequestered into large autophagic vacuoles, positive for the autophagy protein LC3. Autophagy may be targeting irregular membrane shapes and/or aggregated protein. We suggest that membrane morphology can be controlled in cells. |
|
Demontis F, Dahmann C
|
Characterization of the Drosophila ortholog of the human Usher Syndrome type 1G protein sans.
|
PLoS ONE 2009 Mar 09;4(3):e4753
|
|
Developmental Biology
|

|
19270738 |
|
The Usher syndrome (USH) is the most frequent deaf-blindness hereditary disease in humans. Deafness is attributed to the disorganization of stereocilia in the inner ear. USH1, the most severe subtype, is associated with mutations in genes encoding myosin VIIa, harmonin, cadherin 23, protocadherin 15, and sans. Myosin VIIa, harmonin, cadherin 23, and protocadherin 15 physically interact in vitro and localize to stereocilia tips in vivo, indicating that they form functional complexes. Sans, in contrast, localizes to vesicle-like structures beneath the apical membrane of stereocilia-displaying hair cells. How mutations in sans result in deafness and blindness is not well understood. Orthologs of myosin VIIa and protocadherin 15 have been identified in Drosophila melanogaster and their genetic analysis has identified essential roles in auditory perception and microvilli morphogenesis, respectively. |
|
Carvalho L, Stühmer J, Bois JS, Kalaidzidis Y, Lecaudey V, Heisenberg CP
|
Control of convergent yolk syncytial layer nuclear movement in zebrafish.
|
Development 2009 Apr 11;136(8):1305-15
|
|
Developmental Biology
|

|
19279138 |
|
Nuclear movements play an essential role in metazoan development. Although the intracellular transport mechanisms underlying nuclear movements have been studied in detail, relatively little is known about signals from surrounding cells and tissues controlling these movements. Here, we show that, in gastrulating zebrafish embryos, convergence movements of nuclei within the yolk syncytial layer (YSL) are guided by mesoderm and endoderm progenitors migrating along the surface of the yolk towards the dorsal side of the developing gastrula. Progenitor cells direct the convergence movements of internal yolk syncytial nuclei (iYSN) by modulating cortical flow within the YSL in which the iYSN are entrained. The effect of mesoderm and endoderm progenitors on the convergence movement of iYSN depends on the expression of E-cadherin, indicating that adhesive contact between the cells and the YSL is required for the mesendoderm-modulated YSL cortical flow mediating nuclear convergence. In summary, our data reveal a crucial function for cortical flow in the coordination of syncytial nuclear movements with surrounding cells and tissues during zebrafish gastrulation. |
|
Bramsen JB, Laursen MB, Nielsen AF, Hansen TB, Bus C, Langkjaer N, Babu BR, Højland T, Abramov M, Van Aerschot A, Odadzic D, Smicius R, Haas J, Andree C, Barman J, Wenska M, Srivastava P, Zhou C, Honcharenko D, Hess S, Müller E, Bobkov GV, Mikhailov SN, Fava E, Meyer TF, Chattopadhyaya J, Zerial M, Engels JW, Herdewijn P, Wengel J, Kjems J
|
A large-scale chemical modification screen identifies design rules to generate siRNAs with high activity, high stability and low toxicity.
|
Nucleic Acids Res. 2009 May 12;37(9):2867-81
|
|
Imaging Technologies Development
|

|
19282453 |
|
The use of chemically synthesized short interfering RNAs (siRNAs) is currently the method of choice to manipulate gene expression in mammalian cell culture, yet improvements of siRNA design is expectably required for successful application in vivo. Several studies have aimed at improving siRNA performance through the introduction of chemical modifications but a direct comparison of these results is difficult. We have directly compared the effect of 21 types of chemical modifications on siRNA activity and toxicity in a total of 2160 siRNA duplexes. We demonstrate that siRNA activity is primarily enhanced by favouring the incorporation of the intended antisense strand during RNA-induced silencing complex (RISC) loading by modulation of siRNA thermodynamic asymmetry and engineering of siRNA 3'-overhangs. Collectively, our results provide unique insights into the tolerance for chemical modifications and provide a simple guide to successful chemical modification of siRNAs with improved activity, stability and low toxicity. |
|
Marzesco AM, Wilsch-Bräuninger M, Dubreuil V, Janich P, Langenfeld K, Thiele C, Huttner WB, Corbeil D
|
Release of extracellular membrane vesicles from microvilli of epithelial cells is enhanced by depleting membrane cholesterol.
|
FEBS Lett. 2009 Mar 4;583(5):897-902
|
|
Cell Biology
|

|
19302789 |
|
We previously reported on the occurrence of prominin-1-carrying membrane vesicles that are released into body fluids from microvilli of epithelial cells. This release has been implicated in cell differentiation. Here we have characterized these vesicles released from the differentiated Caco-2 cells. We find that in these vesicles, prominin-1 directly interacts with membrane cholesterol and is associated with a membrane microdomain. The cholesterol depletion using methyl-beta-cyclodextrin resulted in a marked increase in their release, and a dramatic change in the microvillar ultrastructure from a tubular shape to a "pearling" state, with multiple membrane constrictions, suggesting a role of membrane cholesterol in vesicle release from microvilli. |
|
Raabe I, Vogel SK, Peychl J, Tolić-Nørrelykke IM
|
Intracellular nanosurgery and cell enucleation using a picosecond laser.
|
J Microsc 2009 Apr;234(1):1-8
|
|
Imaging Technologies Development
|

|
19335451 |
|
Living cells are highly organized in space and time, which makes spatially and temporally confined manipulations an indispensable tool in cell biology. Laser-based nanosurgery is an elegant method that allows precise ablation of intracellular structures. Here, we show cutting of fluorescently labelled microtubules and mitotic spindles in fission yeast, performed with a picosecond laser coupled to a confocal microscope. Diverse effects from photo-bleaching to partial and complete breakage are obtained by varying the exposure time, while simultaneously imaging the structures of interest. Using this system we developed an efficient technique to generate enucleated cells without perturbing the distribution of other organelles. This enucleation method can be used to study the cytoskeleton in a nucleus-free environment, as well as the role of the nucleus in cell growth and a variety of cellular functions. |
|
Fei JF, Huttner WB
|
Nonselective sister chromatid segregation in mouse embryonic neocortical precursor cells.
|
Cereb. Cortex 2009 Jul 02;19 Suppl 1:i49-54
|
|
Neurobiology
|

|
19342402 |
|
We have investigated whether the precursor cells that give rise to the neurons of the neocortex during mouse embryonic development segregate sister chromatids nonrandomly upon mitosis, as would be predicted by the immortal strand hypothesis. Using various protocols of 5-bromo-2-deoxyuridine (BrdU) labeling and chase, we were unable to detect BrdU label-retaining neocortical precursor cells at any of the embryonic stages analyzed, even when the entire brain was analyzed by serial sectioning. Analysis of mitotic neuroepithelial and radial glial cells revealed BrdU-labeled sister chromatid segregation to both nascent daughter cells, which showed a mirror-symmetrical pattern in the first and a non-mirror-symmetrical pattern in the second division after BrdU labeling. Taken together, our data are incompatible with embryonic neocortical precursor cells segregating the sister chromatids selectively to one daughter cell upon mitosis and hence argue against the existence of immortal DNA strands in these cells. In light of the previously reported existence of immortal DNA strands in adult neural stem cells, we discuss that either 1) embryonic and adult neural stem cells in the cortex are distinct or 2) that most, if not all, of the embryonic precursor cells to neocortical neurons are progenitor cells rather than true neural stem cells. |
|
Maghelli N, Tolić-Nørrelykke IM
|
Versatile laser-based cell manipulator.
|
J Biophotonics 2008 Sep;1(4):299-309
|
|
Imaging Technologies Development
|

|
19343653 |
|
Here we describe a two-photon microscope and laser ablation setup combined with optical tweezers. We tested the setup on the fission yeast Schizosaccharomyces pombe, a commonly used model organism. We show that long-term imaging can be achieved without significant photo-bleaching or damage of the sample. The setup can precisely ablate sub-micrometer structures, such as microtubules and mitotic spindles, inside living cells, which remain viable after the manipulation. Longer exposure times lead to ablation, while shorter exposures lead to photo-bleaching of the target structure. We used optical tweezers to trap intracellular particles and to displace the cell nucleus. Two-photon fluorescence imaging of the manipulated cell can be performed simultaneously with trapping. The combination of techniques described here may help to solve a variety of problems in cell biology, such as positioning of organelles and the forces exerted by the cytoskeleton. |
|
Vasileva A, Tiedau D, Firooznia A, Müller-Reichert T, Jessberger R
|
Tdrd6 is required for spermiogenesis, chromatoid body architecture, and regulation of miRNA expression.
|
Curr. Biol. 2009 Apr 28;19(8):630-9
|
|
Cell Biology
|

|
19345099 |
|
Chromatoid bodies (CBs) are characteristic spermatid organelles, which were suggested to function in RNA storage and small RNA processing but whose functions remain largely unknown. CB components include Mili, Miwi, and Tudor domain proteins such as Tdrd6, whose contribution to CB structure and function is elusive. |
|
Ding L, Paszkowski-Rogacz M, Nitzsche A, Slabicki MM, Heninger AK, de Vries I, Kittler R, Junqueira M, Shevchenko A, Schulz H, Hubner N, Doss MX, Sachinidis A, Hescheler J, Iacone R, Anastassiadis K, Stewart AF, Pisabarro MT, Caldarelli A, Poser I, Theis M, Buchholz F
|
A genome-scale RNAi screen for Oct4 modulators defines a role of the Paf1 complex for embryonic stem cell identity.
|
Cell Stem Cell 2009 May 8;4(5):403-15
|
|
Cell Biology
|

|
19345177 |
|
Pluripotent embryonic stem cells (ESCs) maintain self-renewal while ensuring a rapid response to differentiation cues. The identification of genes maintaining ESC identity is important to develop these cells for their potential therapeutic use. Here we report a genome-scale RNAi screen for a global survey of genes affecting ESC identity via alteration of Oct4 expression. Factors with the strongest effect on Oct4 expression included components of the Paf1 complex, a protein complex associated with RNA polymerase II. Using a combination of proteomics, expression profiling, and chromatin immunoprecipitation, we demonstrate that the Paf1C binds to promoters of key pluripotency genes, where it is required to maintain a transcriptionally active chromatin structure. The Paf1C is developmentally regulated and blocks ESC differentiation upon overexpression, and the knockdown in ESCs causes expression changes similar to Oct4 or Nanog depletions. We propose that the Paf1C plays an important role in maintaining ESC identity. |
|
Preibisch S, Saalfeld S, Tomančák P
|
Globally optimal stitching of tiled 3D microscopic image acquisitions.
|
Bioinformatics 2009 Jun 1;25(11):1463-5
|
|
Image Processing
|

|
19346324 |
|
Modern anatomical and developmental studies often require high-resolution imaging of large specimens in three dimensions (3D). Confocal microscopy produces high-resolution 3D images, but is limited by a relatively small field of view compared with the size of large biological specimens. Therefore, motorized stages that move the sample are used to create a tiled scan of the whole specimen. The physical coordinates provided by the microscope stage are not precise enough to allow direct reconstruction (Stitching) of the whole image from individual image stacks. |
|
Bretschneider T, Anderson K, Ecke M, Müller-Taubenberger A, Schroth-Diez B, Ishikawa-Ankerhold HC, Gerisch G
|
The three-dimensional dynamics of actin waves, a model of cytoskeletal self-organization.
|
Biophys. J. 2009 Apr 8;96(7):2888-900
|
|
Biophysics
|

|
19348770 |
|
Actin polymerization is typically initiated at specific sites in a cell by membrane-bound protein complexes, and the resulting structures are involved in specialized cellular functions, such as migration, particle uptake, or mitotic division. Here we analyze the potential of the actin system to self-organize into waves that propagate on the planar, substrate-attached membrane of a cell. We show that self-assembly involves the ordered recruitment of proteins from the cytoplasmic pool and relate the organization of actin waves to their capacity for applying force. Three proteins are shown to form distinct three-dimensional patterns in the actin waves. Myosin-IB is enriched at the wave front and close to the plasma membrane, the Arp2/3 complex is distributed throughout the waves, and coronin forms a sloping layer on top of them. CARMIL, a protein that links myosin-IB to the Arp2/3 complex, is also recruited to the waves. Wave formation does not depend on signals transmitted by heterotrimeric G-proteins, nor does their propagation require SCAR, a regulator upstream of the Arp2/3 complex. Propagation of the waves is based on an actin treadmilling mechanism, indicating a program that couples actin assembly to disassembly in a three-dimensional pattern. When waves impinge on the cell perimeter, they push the edge forward; when they reverse direction, the cell border is paralyzed. These data show that force-generating, highly organized supramolecular networks are autonomously formed in live cells from molecular motors and proteins controlling actin polymerization and depolymerization. |
|
Hermann A, Suess C, Fauser M, Kanzler S, Witt M, Fabel K, Schwarz J, Höglinger GU, Storch A
|
Rostro-caudal gradual loss of cellular diversity within the periventricular regions of the ventricular system.
|
Stem Cells 2009 Apr;27(4):928-41
|
|
Neurobiology
|

|
19353521 |
|
Neurogenesis occurs constitutively within the periventricular region (PVR) of the lateral ventricles (LV) of the adult mammalian brain. The occurrence of adult neurogenesis within the PVR outside the neurogenic niche of the LV remains controversial, but neural stem cells can be isolated from PVR of the whole ventricular system. The histological basis of this phenomenon including the regional differences of cellular phenotypes within the PVRs is still enigmatic. The occurrence of neurogenesis or manipulable progenitor cells in caudal parts of the adult brain is however one prerequisite for orthotopic regenerative approaches in Parkinson's disease (PD) and other disorders of the midbrain/brainstem. Using quantitative immunohistochemical techniques and electron microscopy, we found a rostro-caudal gradual loss of cellular diversity within the PVR throughout the whole ventricular axis with loss of transit amplifying epidermal growth factor-receptor(+) type C cells in all parts caudal to the LV, a gradual reduction from rostral to caudal of both stem cells (type B cells or astrocytes) without signs of proliferation outside the PVR of the LV as well as neuroblasts-like cells (polysialylated neural cell adhesion molecule [PSA-NCAM](+), but doublecortin negative cells) with a different morphology compared with neuroblasts of the PVR of the LV. Electron microscopy confirmed these immunohistochemical data. The proportion of Nestin(+)/CD24(+) cells and Nestin(+)/S100beta(+) ependymal cells were consecutively increased in the PVR from rostral to caudal, and ultrastructural analysis showed a region-specific morphology with darker cytoplasm with occasional large lipid droplets as well as indented nuclei within the caudal PVRs. The strong correlation of neuroblast-like cells with the number of neurosphere-forming cells suggests that a quiescent subtype of PSA-NCAM(+) cells might be a source of neurosphere-forming cells. We did not find any evidence for neurogenesis or the occurrence of neuroprogenitors within the substantia nigra or other parts of the midbrain/brainstem outside the PVR. Our data provide the histological framework for future studies on orthotopic regenerative approaches in PD by recruiting endogenous predopaminergic progenitors from the midbrain PVR. |
|
Widmann TJ, Dahmann C
|
Dpp signaling promotes the cuboidal-to-columnar shape transition of Drosophila wing disc epithelia by regulating Rho1.
|
J. Cell. Sci. 2009 May 1;122(Pt 9):1362-73
|
|
Developmental Biology
|

|
19366729 |
|
Morphogenesis is largely driven by changes in the shape of individual cells. However, how cell shape is regulated in developing animals is not well understood. Here, we show that the onset of TGFbeta/Dpp signaling activity correlates with the transition from cuboidal to columnar cell shape in developing Drosophila melanogaster wing disc epithelia. Dpp signaling is necessary for maintaining this elongated columnar cell shape and overactivation of the Dpp signaling pathway results in precocious cell elongation. Moreover, we provide evidence that Dpp signaling controls the subcellular distribution of the activities of the small GTPase Rho1 and the regulatory light chain of non-muscle myosin II (MRLC). Alteration of Rho1 or MRLC activity has a profound effect on apical-basal cell length. Finally, we demonstrate that a decrease in Rho1 or MRLC activity rescues the shortening of cells with compromised Dpp signaling. Our results identify a cell-autonomous role for Dpp signaling in promoting and maintaining the elongated columnar shape of wing disc cells and suggest that Dpp signaling acts by regulating Rho1 and MRLC. |
|
Benenati G, Penkov S, Müller-Reichert T, Entchev EV, Kurzchalia TV
|
Two cytochrome P450s in Caenorhabditis elegans are essential for the organization of eggshell, correct execution of meiosis and the polarization of embryo.
|
Mech. Dev. 2009 May-Jun;126(5-6):382-93
|
|
Developmental Biology
|

|
19368796 |
|
The role of lipids in the process of embryonic development of Caenorhabditis elegans is still poorly understood. Cytochrome P450s, a class of lipid-modifying enzymes, are good candidates to be involved in the production or degradation of lipids essential for development. We investigated two highly similar cytochrome P450s in C. elegans, cyp-31A2 and cyp-31A3, that are homologs of the gene responsible for Bietti crystalline corneoretinal dystrophy in humans. Depletion of both cytochromes either by RNAi or using a double deletion mutant, led to the failure of establishing the correct polarity of the embryo and to complete the extrusion of the polar bodies during meiosis. In addition, the egg became osmotic sensitive and permeable to dyes. The phenotype of cyp-31A2 or cyp-31A3 is very similar to a class of mutants that have polarization and osmotic defects (POD), thus the genes were renamed to pod-7 and pod-8, respectively. Electron microscopic analysis demonstrated that the activity of pod-7/pod-8 is crucial for the proper assembly of the eggshell and, in particular, for the production of its lipid-rich layer. Using a complementation with lipid extracts, we show that POD-7/POD-8 function together with a NADPH cytochrome P450 reductase, coded by emb-8, and are involved in the production of lipid(s) required for eggshell formation. |
|
Saalfeld S, Cardona A, Hartenstein V, Tomančák P
|
CATMAID: collaborative annotation toolkit for massive amounts of image data.
|
Bioinformatics 2009 Aug 1;25(15):1984-6
|
|
Image Processing
|

|
19376822 |
|
High-resolution, three-dimensional (3D) imaging of large biological specimens generates massive image datasets that are difficult to navigate, annotate and share effectively. Inspired by online mapping applications like GoogleMaps, we developed a decentralized web interface that allows seamless navigation of arbitrarily large image stacks. Our interface provides means for online, collaborative annotation of the biological image data and seamless sharing of regions of interest by bookmarking. The CATMAID interface enables synchronized navigation through multiple registered datasets even at vastly different scales such as in comparisons between optical and electron microscopy. |
|
Vogel SK, Pavin N, Maghelli N, Jülicher F, Tolić-Nørrelykke IM
|
Self-organization of dynein motors generates meiotic nuclear oscillations.
|
PLoS Biol. 2009 Apr 21;7(4):e1000087
|
|
Cell Biology
|

|
19385717 |
|
Meiotic nuclear oscillations in the fission yeast Schizosaccharomyces pombe are crucial for proper chromosome pairing and recombination. We report a mechanism of these oscillations on the basis of collective behavior of dynein motors linking the cell cortex and dynamic microtubules that extend from the spindle pole body in opposite directions. By combining quantitative live cell imaging and laser ablation with a theoretical description, we show that dynein dynamically redistributes in the cell in response to load forces, resulting in more dynein attached to the leading than to the trailing microtubules. The redistribution of motors introduces an asymmetry of motor forces pulling in opposite directions, leading to the generation of oscillations. Our work provides the first direct in vivo observation of self-organized dynamic dynein distributions, which, owing to the intrinsic motor properties, generate regular large-scale movements in the cell. |
|
Theis M, Slabicki M, Junqueira M, Paszkowski-Rogacz M, Sontheimer J, Kittler R, Heninger AK, Glatter T, Kruusmaa K, Poser I, Hyman AA, Pisabarro MT, Gstaiger M, Aebersold R, Shevchenko A, Buchholz F
|
Comparative profiling identifies C13orf3 as a component of the Ska complex required for mammalian cell division.
|
EMBO J. 2009 May 20;28(10):1453-65
|
|
Cell Biology
|

|
19387489 |
|
Proliferation of mammalian cells requires the coordinated function of many proteins to accurately divide a cell into two daughter cells. Several RNAi screens have identified previously uncharacterised genes that are implicated in mammalian cell division. The molecular function for these genes needs to be investigated to place them into pathways. Phenotypic profiling is a useful method to assign putative functions to uncharacterised genes. Here, we show that the analysis of protein localisation is useful to refine a phenotypic profile. We show the utility of this approach by defining a function of the previously uncharacterised gene C13orf3 during cell division. C13orf3 localises to centrosomes, the mitotic spindle, kinetochores, spindle midzone, and the cleavage furrow during cell division and is specifically phosphorylated during mitosis. Furthermore, C13orf3 is required for centrosome integrity and anaphase onset. Depletion by RNAi leads to mitotic arrest in metaphase with an activation of the spindle assembly checkpoint and loss of sister chromatid cohesion. Proteomic analyses identify C13orf3 (Ska3) as a new component of the Ska complex and show a direct interaction with a regulatory subunit of the protein phosphatase PP2A. All together, these data identify C13orf3 as an important factor for metaphase to anaphase progression and highlight the potential of combined RNAi screening and protein localisation analyses. |
|
Sapra AK, Ankö ML, Grishina I, Lorenz M, Pabis M, Poser I, Rollins J, Weiland EM, Neugebauer KM
|
SR protein family members display diverse activities in the formation of nascent and mature mRNPs in vivo.
|
Mol. Cell 2009 Apr 24;34(2):179-90
|
|
Cell Biology
|

|
19394295 |
|
The SR proteins are a family of pre-mRNA splicing factors with additional roles in gene regulation. To investigate individual family members in vivo, we generated a comprehensive panel of stable cell lines expressing GFP-tagged SR proteins under endogenous promoter control. Recruitment of SR proteins to nascent FOS RNA was transcription dependent and RNase sensitive, with unique patterns of accumulation along the gene specified by the RNA recognition motifs (RRMs). In addition, all SR protein interactions with Pol II were RNA dependent, indicating that SR proteins are not preassembled with Pol II. SR protein interactions with RNA were confirmed in situ by FRET/FLIM. Interestingly, SC35-GFP also exhibited FRET with DNA and failed to associate with cytoplasmic mRNAs, whereas all other SR proteins underwent nucleocytoplasmic shuttling and associated with specific nuclear and cytoplasmic mRNAs. Because different constellations of SR proteins bound nascent, nuclear, and cytoplasmic mRNAs, mRNP remodeling must occur throughout an mRNA's lifetime. |
|
Pulvers JN, Huttner WB
|
Brca1 is required for embryonic development of the mouse cerebral cortex to normal size by preventing apoptosis of early neural progenitors.
|
Development 2009 Jun 29;136(11):1859-68
|
|
Neurobiology
|

|
19403657 |
|
The extent of apoptosis of neural progenitors is known to influence the size of the cerebral cortex. Mouse embryos lacking Brca1, the ortholog of the human breast cancer susceptibility gene BRCA1, show apoptosis in the neural tube, but the consequences of this for brain development have not been studied. Here we investigated the role of Brca1 during mouse embryonic cortical development by deleting floxed Brca1 using Emx1-Cre, which leads to conditional gene ablation specifically in the dorsal telencephalon after embryonic day (E) 9.5. The postnatal Brca1-ablated cerebral cortex was substantially reduced in size with regard to both cortical thickness and surface area. Remarkably, although the thickness of the cortical layers (except for the upper-most layer) was decreased, cortical layering as such was essentially unperturbed. High levels of apoptosis were found at E11.5 and E13.5, but dropped to near-control levels by E16.5. The apoptosis at the early stage of neurogenesis occurred in both BrdU pulse-labeled neural progenitors and the neurons derived therefrom. No changes were observed in the mitotic index of apical (neuroepithelial, radial glial) progenitors and basal (intermediate) progenitors, indicating that Brca1 ablation did not affect cell cycle progression. Brca1 ablation did, however, result in the nuclear translocation of p53 in neural progenitors, suggesting that their apoptosis involved activation of the p53 pathway. Our results show that Brca1 is required for the cerebral cortex to develop to normal size by preventing the apoptosis of early cortical progenitors and their immediate progeny. |
|
Saito K, Dubreuil V, Arai Y, Wilsch-Bräuninger M, Schwudke D, Saher G, Miyata T, Breier G, Thiele C, Shevchenko A, Nave KA, Huttner WB
|
Ablation of cholesterol biosynthesis in neural stem cells increases their VEGF expression and angiogenesis but causes neuron apoptosis.
|
Proc. Natl. Acad. Sci. U.S.A. 2009 May 19;106(20):8350-5
|
|
Neurobiology
|

|
19416849 |
|
Although sufficient cholesterol supply is known to be crucial for neurons in the developing mammalian brain, the cholesterol requirement of neural stem and progenitor cells in the embryonic central nervous system has not been addressed. Here we have conditionally ablated the activity of squalene synthase (SQS), a key enzyme for endogenous cholesterol production, in the neural stem and progenitor cells of the ventricular zone (VZ) of the embryonic mouse brain. Mutant embryos exhibited a reduced brain size due to the atrophy of the neuronal layers, and died at birth. Analyses of the E11.5-E15.5 dorsal telencephalon and diencephalon revealed that this atrophy was due to massive apoptosis of newborn neurons, implying that this progeny of the SQS-ablated neural stem and progenitor cells was dependent on endogenous cholesterol biosynthesis for survival. Interestingly, the neural stem and progenitor cells of the VZ, the primary target of SQS inactivation, did not undergo significant apoptosis. Instead, vascular endothelial growth factor (VEGF) expression in these cells was strongly upregulated via a hypoxia-inducible factor-1-independent pathway, and angiogenesis in the VZ was increased. Consistent with an increased supply of lipoproteins to these cells, the level of lipid droplets containing triacylglycerides with unsaturated fatty acyl chains was found to be elevated. Our study establishes a direct link between intracellular cholesterol levels, VEGF expression, and angiogenesis. Moreover, our data reveal a hitherto unknown compensatory process by which the neural stem and progenitor cells of the developing mammalian brain evade the detrimental consequences of impaired endogenous cholesterol biosynthesis. |
|
Lawo S, Bashkurov M, Mullin M, Ferreria MG, Kittler R, Habermann B, Tagliaferro A, Poser I, Hutchins JR, Hegemann B, Pinchev D, Buchholz F, Peters JM, Hyman AA, Gingras AC, Pelletier L
|
HAUS, the 8-subunit human Augmin complex, regulates centrosome and spindle integrity.
|
Curr. Biol. 2009 May 26;19(10):816-26
|
|
Cell Biology
|

|
19427217 |
|
The assembly of a robust microtubule-based mitotic spindle is a prerequisite for the accurate segregation of chromosomes to progeny. Spindle assembly relies on the concerted action of centrosomes, spindle microtubules, molecular motors, and nonmotor spindle proteins. |
|
Klemm RW, Ejsing CS, Surma MA, Kaiser HJ, Gerl MJ, Sampaio JL, de Robillard Q, Ferguson C, Proszynski TJ, Shevchenko A, Simons K
|
Segregation of sphingolipids and sterols during formation of secretory vesicles at the trans-Golgi network.
|
J. Cell Biol. 2009 May 18;185(4):601-12
|
|
Cell Biology
|

|
19433450 |
|
The trans-Golgi network (TGN) is the major sorting station in the secretory pathway of all eukaryotic cells. How the TGN sorts proteins and lipids to generate the enrichment of sphingolipids and sterols at the plasma membrane is poorly understood. To address this fundamental question in membrane trafficking, we devised an immunoisolation procedure for specific recovery of post-Golgi secretory vesicles transporting a transmembrane raft protein from the TGN to the cell surface in the yeast Saccharomyces cerevisiae. Using a novel quantitative shotgun lipidomics approach, we could demonstrate that TGN sorting selectively enriched ergosterol and sphingolipid species in the immunoisolated secretory vesicles. This finding, for the first time, indicates that the TGN exhibits the capacity to sort membrane lipids. Furthermore, the observation that the immunoisolated vesicles exhibited a higher membrane order than the late Golgi membrane, as measured by C-Laurdan spectrophotometry, strongly suggests that lipid rafts play a role in the TGN-sorting machinery. |
|
Kaslin J, Ganz J, Geffarth M, Grandel H, Hans S, Brand M
|
Stem cells in the adult zebrafish cerebellum: initiation and maintenance of a novel stem cell niche.
|
J. Neurosci. 2009 May 13;29(19):6142-53
|
|
Neurobiology
|

|
19439592 |
|
In the adult CNS, neurogenesis takes place in special niches. It is not understood how these niches are formed during development and how they are maintained. In contrast to mammals, stem cell niches are abundant in zebrafish and also found in other parts of the brain than telencephalon. To understand common characteristics of neural stem cell niches in vertebrates, we studied the origin and architecture of a previously unknown stem cell niche using transgenic lines, in vivo imaging, and marker analysis. We show that bipotent stem cells are maintained in a distinct niche in the adult zebrafish cerebellum. Remarkably, the stem cells are not typical glia but instead retain neuroepithelial characteristics. The cerebellar stem cell niche is generated by the coordinated displacement of ventricle and rhombic lip progenitors in a two-step process involving morphogenetic movements and tissue growth. Importantly, the niche and its stem cells still remain in ventricular contact through a previously unknown derivative of the ventricle. Factors propagated in the ventricle are thought to be important regulators of stem cell activity. To test the requirements of one family of important factors, Fibroblast growth factors, we used zebrafish with an inducible dominant-negative Fgf receptor. Inhibition of Fgf signaling leads to significant reduction of stem cell activity. In contrast to the predominant view, adult neural stem cells in nonmammalian vertebrates show more neuroepithelial than glial characteristics. Nevertheless, retained epithelial properties such as distinct polarization and ventricular contact are critical common determinants to maintain neural stem cell activity in vertebrates. |
|
Baumgärtner S, Tolić-Nørrelykke IM.
|
Growth pattern of single fission yeast cells is bilinear and depends on temperature and DNA synthesis.
|
Biophys. J. 2009 May 20;96(10):4336-47
|
|
Biophysics
|

|
19450504 |
|
Cell growth and division have to be tightly coordinated to keep the cell size constant over generations. Changes in cell size can be easily studied in the fission yeast Schizosaccharomyces pombe because these cells have a cylindrical shape and grow only at the cell ends. However, the growth pattern of single cells is currently unclear. Linear, exponential, and bilinear growth models have been proposed. Here we measured the length of single fission yeast cells with high spatial precision and temporal resolution over the whole cell cycle by using time-lapse confocal microscopy of cells with green fluorescent protein-labeled plasma membrane. We show that the growth profile between cell separation and the subsequent mitosis is bilinear, consisting of two linear segments separated by a rate-change point (RCP). The change in growth rate occurred at the same relative time during the cell cycle and at the same relative extension for different temperatures. The growth rate before the RCP was independent of temperature, whereas the growth rate after the RCP increased with an increase in temperature, leading to clear bilinear growth profiles at higher temperatures. The RCP was not directly related to the initiation of growth at the new end (new end take-off). When DNA synthesis was inhibited by hydroxyurea, the RCP was not detected. This result suggests that completion of DNA synthesis is required for the increase in growth rate. We conclude that the growth of fission yeast cells is not a simple exponential growth, but a complex process with precise rates regulated by the events during the cell cycle. |
|
Ohya T, Miaczynska M, Coskun U, Lommer B, Runge A, Drechsel D, Kalaidzidis Y, Zerial M
|
Reconstitution of Rab- and SNARE-dependent membrane fusion by synthetic endosomes.
|
Nature 2009 Jun 25;459(7250):1091-7
|
|
Cell Biology
|

|
19458617 |
|
Rab GTPases and SNAREs (soluble N-ethylmaleimide-sensitive factor attachment protein receptors) are evolutionarily conserved essential components of the eukaryotic intracellular transport system. Although pairing of cognate SNAREs is sufficient to fuse membranes in vitro, a complete reconstitution of the Rab-SNARE machinery has never been achieved. Here we report the reconstitution of the early endosomal canine Rab5 GTPase, its key regulators and effectors together with SNAREs into proteoliposomes using a set of 17 recombinant human proteins. These vesicles behave like minimal 'synthetic' endosomes, fusing with purified early endosomes or with each other in vitro. Membrane fusion measured by content-mixing and morphological assays requires the cooperativity between Rab5 effectors and cognate SNAREs which, together, form a more efficient 'core machinery' than SNAREs alone. In reconstituting a fusion mechanism dependent on both a Rab GTPase and SNAREs, our work shows that the two machineries act coordinately to increase the specificity and efficiency of the membrane tethering and fusion process. |
|
Brangwynne CP, Eckmann CR, Courson DS, Rybarska A, Hoege C, Gharakhani J, Jülicher F, Hyman AA
|
Germline P granules are liquid droplets that localize by controlled dissolution/condensation.
|
Science 2009 Jun 26;324(5935):1729-32
|
|
Biophysics
|

|
19460965 |
|
In sexually reproducing organisms, embryos specify germ cells, which ultimately generate sperm and eggs. In Caenorhabditis elegans, the first germ cell is established when RNA and protein-rich P granules localize to the posterior of the one-cell embryo. Localization of P granules and their physical nature remain poorly understood. Here we show that P granules exhibit liquid-like behaviors, including fusion, dripping, and wetting, which we used to estimate their viscosity and surface tension. As with other liquids, P granules rapidly dissolved and condensed. Localization occurred by a biased increase in P granule condensation at the posterior. This process reflects a classic phase transition, in which polarity proteins vary the condensation point across the cell. Such phase transitions may represent a fundamental physicochemical mechanism for structuring the cytoplasm. |
|
Rybarska A, Harterink M, Jedamzik B, Kupinski AP, Schmid M, Eckmann CR
|
GLS-1, a novel P granule component, modulates a network of conserved RNA regulators to influence germ cell fate decisions.
|
PLoS Genet. 2009 May 22;5(5):e1000494
|
|
Cell Biology
|

|
19461891 |
|
Post-transcriptional regulatory mechanisms are widely used to influence cell fate decisions in germ cells, early embryos, and neurons. Many conserved cytoplasmic RNA regulatory proteins associate with each other and assemble on target mRNAs, forming ribonucleoprotein (RNP) complexes, to control the mRNAs translational output. How these RNA regulatory networks are orchestrated during development to regulate cell fate decisions remains elusive. We addressed this problem by focusing on Caenorhabditis elegans germline development, an exemplar of post-transcriptional control mechanisms. Here, we report the discovery of GLS-1, a new factor required for many aspects of germline development, including the oocyte cell fate in hermaphrodites and germline survival. We find that GLS-1 is a cytoplasmic protein that localizes in germ cells dynamically to germplasm (P) granules. Furthermore, its functions depend on its ability to form a protein complex with the RNA-binding Bicaudal-C ortholog GLD-3, a translational activator and P granule component important for similar germ cell fate decisions. Based on genetic epistasis experiments and in vitro competition experiments, we suggest that GLS-1 releases FBF/Pumilio from GLD-3 repression. This facilitates the sperm-to-oocyte switch, as liberated FBF represses the translation of mRNAs encoding spermatogenesis-promoting factors. Our proposed molecular mechanism is based on the GLS-1 protein acting as a molecular mimic of FBF/Pumilio. Furthermore, we suggest that a maternal GLS-1/GLD-3 complex in early embryos promotes the expression of mRNAs encoding germline survival factors. Our work identifies GLS-1 as a fundamental regulator of germline development. GLS-1 directs germ cell fate decisions by modulating the availability and activity of a single translational network component, GLD-3. Hence, the elucidation of the mechanisms underlying GLS-1 functions provides a new example of how conserved machinery can be developmentally manipulated to influence cell fate decisions and tissue development. |
|
Ejsmont RK, Sarov M, Winkler S, Lipinski KA, Tomancak P
|
A toolkit for high-throughput, cross-species gene engineering in Drosophila.
|
Nat. Methods 2009 Jun;6(6):435-7
|
|
Imaging Technologies Development
|

|
19465918 |
|
We generated two complementary genomic fosmid libraries for Drosophila melanogaster and Drosophila pseudoobscura that permit seamless modification of large genomic clones by high-throughput recombineering and direct transgenesis. The fosmid transgenes recapitulated endogenous gene expression patterns. These libraries, in combination with recombineering technology, will be useful to rescue mutant phenotypes, allow imaging of gene products in living flies and enable systematic analysis and manipulation of gene activity across species. |
|
O'Toole E, Müller-Reichert T
|
Electron tomography of microtubule end-morphologies in C. elegans embryos.
|
Methods Mol. Biol. 2009;545:135-44
|
|
Imaging Technologies Development
|

|
19475386 |
|
In this chapter we describe the preparation of early mitotic C. elegans embryos for the tomographic reconstruction of end-morphologies of spindle microtubules. Early embryos are prepared by high-pressure freezing and freeze-substitution for thin-layer embedding in Epon/Araldite. We further describe data acquisition, tomographic reconstruction, and 3-D modeling of microtubules in serially sectioned mitotic spindles. The presented techniques are applicable to other model systems. |
|
Attardo A, Fabel K, Krebs J, Haubensak W, Huttner WB, Kempermann G
|
Tis21 expression marks not only populations of neurogenic precursor cells but also new postmitotic neurons in adult hippocampal neurogenesis.
|
Cereb. Cortex 2010 Feb 29;20(2):304-14
|
|
Neurobiology
|

|
19482889 |
|
During embryonic cortical development, expression of Tis21 is associated with cell cycle lengthening and neurogenic divisions of progenitor cells. We here investigated if the expression pattern of Tis21 also correlates with the generation of new neurons in the adult hippocampus. We used Tis21 knock-in mice expressing green fluorescent protein (GFP) and studied Tis21-GFP expression together with markers of adult hippocampal neurogenesis in newly generated cells. We found that Tis21-GFP 1) was absent from the radial glia-like putative stem cells (type-1 cells), 2) first appeared in transient amplifying progenitor cells (type-2 and 3 cells), 3) did not colocalize with markers of early postmitotic maturation stage, 4) was expressed again in maturing neurons, and 5) finally decreased in mature granule cells. Our data show that, in the course of adult neurogenesis, Tis21 is expressed in a phase additional to the one of the embryonic neurogenesis. This additional phase of expression might be associated with a new and different function of Tis21 than during embryonic brain development, where no Tis21 is expressed in mature neurons. We hypothesize that this function is related to the final functional integration of the newborn neurons. Tis21 can thus serve as new marker for key stages of adult neurogenesis. |
|
Cambridge SB, Geissler D, Calegari F, Anastassiadis K, Hasan MT, Stewart AF, Huttner WB, Hagen V, Bonhoeffer T
|
Doxycycline-dependent photoactivated gene expression in eukaryotic systems.
|
Nat. Methods 2009 Jul 07;6(7):527-31
|
|
Cell Biology
|

|
19503080 |
|
High spatial and temporal resolution of conditional gene expression is typically difficult to achieve in whole tissues or organisms. We synthesized two reversibly inhibited, photoactivatable ('caged') doxycycline derivatives with different membrane permeabilities for precise spatial and temporal light-controlled activation of transgenes based on the 'Tet-on' system. After incubation with caged doxycycline or caged cyanodoxycycline, we induced gene expression by local irradiation with UV light or by two-photon uncaging in diverse biological systems, including mouse organotypic brain cultures, developing mouse embryos and Xenopus laevis tadpoles. The amount of UV light needed for induction was harmless as we detected no signs of toxicity. This method allows high-resolution conditional transgene expression at different spatial scales, ranging from single cells to entire complex organisms. |
|
Niederlein A, Meyenhofer F, White D, Bickle M
|
Image analysis in high-content screening.
|
Comb. Chem. High Throughput Screen. 2009 Nov;12(9):899-907
|
- LMF MPI-CBG
- Screening MPI-CBG
|
Image Processing
|

|
19531001 |
|
The field of High Content Screening (HCS) has evolved from a technology used exclusively by the pharmaceutical industry for secondary drug screening, to a technology used for primary drug screening and basic research in academia. The size and the complexity of the screens have been steadily increasing. This is reflected in the fact that the major challenges facing the field at the present are data mining and data storage due to the large amount of data generated during HCS. On the one hand, technological progress of fully automated image acquisition platforms, and on the other hand advances in the field of automated image analysis have made this technology more powerful and more accessible to less specialized users. Image analysis solutions for many biological problems exist and more are being developed to increase both the quality and the quantity of data extracted from the images acquired during the screens. We highlight in this review some of the major challenges facing automatic high throughput image analysis and present some of the software solutions available on the market or from academic open source solutions. |
|
Hannich JT, Entchev EV, Mende F, Boytchev H, Martin R, Zagoriy V, Theumer G, Riezman I, Riezman H, Knölker HJ, Kurzchalia TV
|
Methylation of the sterol nucleus by STRM-1 regulates dauer larva formation in Caenorhabditis elegans.
|
Dev. Cell 2009 Jun;16(6):833-43
|
|
Developmental Biology
|

|
19531354 |
|
In response to pheromone(s), Caenorhabditis elegans interrupts its reproductive life cycle and enters diapause as a stress-resistant dauer larva. This decision is governed by a complex system of neuronal and hormonal regulation. All the signals converge onto the nuclear hormone receptor DAF-12. A sterol-derived hormone, dafachronic acid (DA), supports reproductive development by binding to DAF-12 and inhibiting its dauer-promoting activity. Here, we identify a methyltransferase, STRM-1, that modulates DA levels and thus dauer formation. By modifying the substrates that are used for the synthesis of DA, STRM-1 can reduce the amount of hormone produced. Loss of STRM-1 function leads to elevated levels of DA and inefficient dauer formation. Sterol methylation was not previously recognized as a mechanism for regulating hormone activity. Moreover, the C-4 sterol nucleus methylation catalyzed by STRM-1 is unique to nematodes and thus could be a target for therapeutic strategies against parasitic nematode infections. |
|
Ozkucur N, Richter E, Wetzel C, Funk RH, Monsees TK
|
Biological relevance of ion energy in performance of human endothelial cells on ion-implanted flexible polyurethane surfaces.
|
J Biomed Mater Res A 2010 Apr;93(1):258-68
|
|
Medical Biology
|

|
19557788 |
|
To improve the biocompatibility of polyurethane (PUR), we modified the surface by irradiation with different ions (Carbon; C, Oxygen; O, Nitrogen; N, or Argon; Ar) at 0.3-50 keV energy and doses of 1,00E+13 - 1,00E+15 ions/cm(2). The effects of ion implantation using different ion energies and densities were observed on adhesion, proliferation, and viability of human umbilical vein endothelial cells (HUVECs). The long-term in vitro stability of ion-implanted PUR was also investigated. Ion irradiation moderately affected the surface roughness (R(a)), but strongly enhanced the work of adhesion (W(a)). Cell adhesion was markedly improved on O-, N-, and Ar-, but not on C-implanted PUR surfaces. Medium ion energies and lower ion doses produced the best HUVEC attachment and proliferation, indicating the importance of choosing the proper range of energy applied during ion irradiation. In addition, apoptosis rates were significantly reduced when compared with unmodified PUR (uPUR). N implantation significantly protected the surface, although C implantation led to stronger surface erosions than on uPUR. In total, ion implantation on flexible PUR surfaces strongly improved the material surface characteristics and biocompatibility. Electron beam ion implantation within an appropriate energy window is thus a key to improving flexible PUR surfaces for clinical use to support endothelial cell performance. Thus, it can contribute to designing small-diameter grafts, which are in great demand, towards vascular tissue engineering applications. |
|
Kragl M, Knapp D, Nacu E, Khattak S, Maden M, Epperlein HH, Tanaka EM
|
Cells keep a memory of their tissue origin during axolotl limb regeneration.
|
Nature 2009 Jul 2;460(7251):60-5
|
|
Developmental Biology
|

|
19571878 |
|
During limb regeneration adult tissue is converted into a zone of undifferentiated progenitors called the blastema that reforms the diverse tissues of the limb. Previous experiments have led to wide acceptance that limb tissues dedifferentiate to form pluripotent cells. Here we have reexamined this question using an integrated GFP transgene to track the major limb tissues during limb regeneration in the salamander Ambystoma mexicanum (the axolotl). Surprisingly, we find that each tissue produces progenitor cells with restricted potential. Therefore, the blastema is a heterogeneous collection of restricted progenitor cells. On the basis of these findings, we further demonstrate that positional identity is a cell-type-specific property of blastema cells, in which cartilage-derived blastema cells harbour positional identity but Schwann-derived cells do not. Our results show that the complex phenomenon of limb regeneration can be achieved without complete dedifferentiation to a pluripotent state, a conclusion with important implications for regenerative medicine. |
|
Lingwood D, Schuck S, Ferguson C, Gerl M, Simons K
|
Morphological homeostasis by autophagy.
|
Autophagy 2009 Oct 19;5(7):1039-40
|
|
Cell Biology
|
|
19587538 |
|
With cellular organelles coming in all shapes and sizes, the principle 'form follows function' is readily discernible through the cytologist's lens. Architecturally, one might ask whether there is feedback in this organization. Does a cell 'know' when it has constructed membrane into the stacks of the Golgi, the cisternae of the mitochondria or the tubules of the endoplasmic reticulum? Proofreading can occur in vivo as both errors in nucleic acids and misfolds in proteins are recognized by the cell. Are there analogous systems which maintain/regulate the architectural integrity of organelles? Our recent paper entitled Generation of cubic membranes from controlled homotypic interactions of membrane proteins in the endoplasmic reticulum suggests that autophagy may play such a role. |
|
Chung KF, Sicard F, Vukicevic V, Hermann A, Storch A, Huttner WB, Bornstein SR, Ehrhart-Bornstein M
|
Isolation of neural crest derived chromaffin progenitors from adult adrenal medulla.
|
Stem Cells 2009 Oct;27(10):2602-13
|
|
Neurobiology
|

|
19609938 |
|
Chromaffin cells of the adrenal medulla are neural crest-derived cells of the sympathoadrenal lineage. Unlike the closely-related sympathetic neurons, a subpopulation of proliferation-competent cells exists even in the adult. Here, we describe the isolation, expansion, and in vitro characterization of proliferation-competent progenitor cells from the bovine adrenal medulla. Similar to neurospheres, these cells, when prevented from adherence to the culture dish, grew in spheres, which we named chromospheres. These chromospheres were devoid of mRNA specific for smooth muscle cells (MYH11) or endothelial cells (PECAM1). During sphere formation, markers for differentiated chromaffin cells, such as phenylethanolamine-N-methyl transferase, were downregulated while neural progenitor markers nestin, vimentin, musashi 1, and nerve growth factor receptor, as well as markers of neural crest progenitor cells such as Sox1 and Sox9, were upregulated. Clonal analysis and bromo-2'-deoxyuridine-incorporation analysis demonstrated the self-renewing capacity of chromosphere cells. Differentiation protocols using NGF and BMP4 or dexamethasone induced neuronal or endocrine differentiation, respectively. Electrophysiological analyses of neural cells derived from chromospheres revealed functional properties of mature nerve cells, such as tetrodotoxin-sensitive sodium channels and action potentials. Our study provides evidence that proliferation and differentiation competent chromaffin progenitor cells can be isolated from adult adrenal medulla and that these cells might harbor the potential for the treatment of neurodegenerative diseases, such as Parkinson's disease. |
|
Widmann TJ, Dahmann C
|
Wingless signaling and the control of cell shape in Drosophila wing imaginal discs.
|
Dev. Biol. 2009 Oct 1;334(1):161-73
|
|
Developmental Biology
|

|
19627985 |
|
The control of cell morphology is important for shaping animals during development. Here we address the role of the Wnt/Wingless signal transduction pathway and two of its target genes, vestigial and shotgun (encoding E-cadherin), in controlling the columnar shape of Drosophila wing disc cells. We show that clones of cells mutant for arrow (encoding an essential component of the Wingless signal transduction pathway), vestigial or shotgun undergo profound cell shape changes and are extruded towards the basal side of the epithelium. Compartment-wide expression of a dominant-negative form of the Wingless transducer T-cell factor (TCF/Pangolin), or double-stranded RNA targeting vestigial or shotgun, leads to abnormally short cells throughout this region, indicating that these genes act cell autonomously to maintain normal columnar cell shape. Conversely, overexpression of Wingless, a constitutively-active form of the Wingless transducer beta-catenin/Armadillo, or Vestigial, results in precocious cell elongation. Co-expression of Vestigial partially suppresses the abnormal cell shape induced by dominant-negative TCF. We conclude that Wingless signal transduction plays a cell-autonomous role in promoting and maintaining the columnar shape of wing disc cells. Furthermore, our data suggest that Wingless controls cell shape, in part, through maintaining vestigial expression. |
|
Richard M, Muschalik N, Grawe F, Ozüyaman S, Knust E
|
A role for the extracellular domain of Crumbs in morphogenesis of Drosophila photoreceptor cells.
|
Eur. J. Cell Biol. 2009 Dec 29;88(12):765-77
|
|
Developmental Biology
|

|
19717208 |
|
Morphogenesis of Drosophila photoreceptor cells includes the subdivision of the apical membrane into the photosensitive rhabdomere and the associated stalk membrane, as well as a considerable elongation of the cell. Drosophila Crumbs (Crb), an evolutionarily conserved transmembrane protein, organizes an apical protein scaffold, which is required for elongation of the photoreceptor cell and extension of the stalk membrane. To further elucidate the role played by different Crb domains during eye morphogenesis, we performed a structure-function analysis in the eye. The analysis showed that the three variants tested, namely full-length Crb, the membrane-bound intracellular domain and the extracellular domain were able to rescue the elongation defects of crb mutant rhabdomeres. However, only full-length Crb and the membrane-bound intracellular domain could partially restore the length of the stalk membrane, while the extracellular domain failed to do so. This failure was associated with the inability of the extracellular domain to recruit beta(Heavy)-spectrin to the stalk membrane. These results highlight the functional importance of the extracellular domain of Crb in the Drosophila eye. They are in line with previous observations, which showed that mutations in the extracellular domain of human CRB1 are associated with retinitis pigmentosa 12 and Leber congenital amaurosis, two severe forms of retinal dystrophy. |
|
Lange C, Huttner WB, Calegari F
|
Cdk4/cyclinD1 overexpression in neural stem cells shortens G1, delays neurogenesis, and promotes the generation and expansion of basal progenitors.
|
Cell Stem Cell 2009 Sep 4;5(3):320-31
|
|
Neurobiology
|

|
19733543 |
|
During mouse embryonic development, neural progenitors lengthen the G1 phase of the cell cycle and this has been suggested to be a cause, rather than a consequence, of neurogenesis. To investigate whether G1 lengthening alone may cause the switch of cortical progenitors from proliferation to neurogenesis, we manipulated the expression of cdk/cyclin complexes and found that cdk4/cyclinD1 overexpression prevents G1 lengthening without affecting cell growth, cleavage plane, or cell cycle synchrony with interkinetic nuclear migration. Specifically, overexpression of cdk4/cyclinD1 inhibited neurogenesis while increasing the generation and expansion of basal (intermediate) progenitors, resulting in a thicker subventricular zone and larger surface area of the postnatal cortex originating from cdk4/cyclinD1-transfected progenitors. Conversely, lengthening of G1 by cdk4/cyclinD1-RNAi displayed the opposite effects. Thus, G1 lengthening is necessary and sufficient to switch neural progenitors to neurogenesis, and overexpression of cdk4/cyclinD1 can be used to increase progenitor expansion and, perhaps, cortical surface area. |
|
Spandl J, White DJ, Peychl J, Thiele C
|
Live cell multicolor imaging of lipid droplets with a new dye, LD540.
|
Traffic 2009 Nov 02;10(11):1579-84
|
|
Imaging Technologies Development
|

|
19765264 |
|
A lipophilic dye based on the Bodipy fluorophore, LD540, was developed for microscopic imaging of lipid droplets. In contrast to previous lipid droplet dyes, it can spectrally be resolved from both green and red fluorophores allowing multicolor imaging in both fixed and living cells. Its improved specificity, brightness and photostability support live cell imaging, which was used to demonstrate by two-color imaging lipid droplet motility along microtubules. |
|
Schenk J, Wilsch-Bräuninger M, Calegari F, Huttner WB
|
Myosin II is required for interkinetic nuclear migration of neural progenitors.
|
Proc. Natl. Acad. Sci. U.S.A. 2009 Sep 22;106(38):16487-92
|
|
Cell Biology
|

|
19805325 |
|
Interkinetic nuclear migration (INM) is a hallmark of the polarized stem and progenitor cells in the ventricular zone (VZ) of the developing vertebrate CNS. INM is responsible for the pseudostratification of the VZ, a crucial aspect of brain evolution. The nuclear migration toward the apical centrosomes in G2 is thought to be a dynein-microtubule-based process. By contrast, the cytoskeletal machinery involved in the basally directed nuclear translocation away from the centrosome in G1 has been enigmatic. Studying the latter aspect of INM requires manipulation of the cytoskeleton without impairing mitosis and cytokinesis. To this end, we have established a culture system of mouse embryonic telencephalon that reproduces cortical development, and have applied it to explore a role of actomyosin in INM. Using the nonmuscle myosin II inhibitor blebbistatin at a low concentration at which neither cell cycle progression nor cytokinesis is impaired, we show that myosin II is required for the apical-to-basal (ap-->bl), ab-centrosomal INM. Myosin II activity is also necessary for the nuclear translocation during delamination of subventricular zone (SVZ) cells, a second, telencephalon-specific type of neural progenitor. Moreover, the inhibition of ab-centrosomal INM changes the balance between VZ and SVZ progenitor cell fate. Our data suggest a unifying concept in which the actomyosin contraction underlying ab-centrosomal INM sets the stage for the evolutionary increase in VZ pseudostratification and for SVZ progenitor delamination, a key process in cortical expansion. |
|
Kaiser HJ, Lingwood D, Levental I, Sampaio JL, Kalvodova L, Rajendran L, Simons K
|
Order of lipid phases in model and plasma membranes.
|
Proc. Natl. Acad. Sci. U.S.A. 2009 Sep 29;106(39):16645-50
|
|
Cell Biology
|

|
19805351 |
|
Lipid rafts are nanoscopic assemblies of sphingolipids, cholesterol, and specific membrane proteins that contribute to lateral heterogeneity in eukaryotic membranes. Separation of artificial membranes into liquid-ordered (Lo) and liquid-disordered phases is regarded as a common model for this compartmentalization. However, tight lipid packing in Lo phases seems to conflict with efficient partitioning of raft-associated transmembrane (TM) proteins. To assess membrane order as a component of raft organization, we performed fluorescence spectroscopy and microscopy with the membrane probes Laurdan and C-laurdan. First, we assessed lipid packing in model membranes of various compositions and found cholesterol and acyl chain dependence of membrane order. Then we probed cell membranes by using two novel systems that exhibit inducible phase separation: giant plasma membrane vesicles [Baumgart et al. (2007) Proc Natl Acad Sci USA 104:3165-3170] and plasma membrane spheres. Notably, only the latter support selective inclusion of raft TM proteins with the ganglioside GM1 into one phase. We measured comparable small differences in order between the separated phases of both biomembranes. Lateral packing in the ordered phase of giant plasma membrane vesicles resembled the Lo domain of model membranes, whereas the GM1 phase in plasma membrane spheres exhibited considerably lower order, consistent with different partitioning of lipid and TM protein markers. Thus, lipid-mediated coalescence of the GM1 raft domain seems to be distinct from the formation of a Lo phase, suggesting additional interactions between proteins and lipids to be effective. |
|
Picker A, Cavodeassi F, Machate A, Bernauer S, Hans S, Abe G, Kawakami K, Wilson SW, Brand M
|
Dynamic coupling of pattern formation and morphogenesis in the developing vertebrate retina.
|
PLoS Biol. 2009 Oct 13;7(10):e1000214
|
|
Developmental Biology
|

|
19823566 |
|
During embryonic development, pattern formation must be tightly synchronized with tissue morphogenesis to coordinate the establishment of the spatial identities of cells with their movements. In the vertebrate retina, patterning along the dorsal-ventral and nasal-temporal (anterior-posterior) axes is required for correct spatial representation in the retinotectal map. However, it is unknown how specification of axial cell positions in the retina occurs during the complex process of early eye morphogenesis. Studying zebrafish embryos, we show that morphogenetic tissue rearrangements during eye evagination result in progenitor cells in the nasal half of the retina primordium being brought into proximity to the sources of three fibroblast growth factors, Fgf8/3/24, outside the eye. Triple-mutant analysis shows that this combined Fgf signal fully controls nasal retina identity by regulating the nasal transcription factor Foxg1. Surprisingly, nasal-temporal axis specification occurs very early along the dorsal-ventral axis of the evaginating eye. By in vivo imaging GFP-tagged retinal progenitor cells, we find that subsequent eye morphogenesis requires gradual tissue compaction in the nasal half and directed cell movements into the temporal half of the retina. Balancing these processes drives the progressive alignment of the nasal-temporal retina axis with the anterior-posterior body axis and is controlled by a feed-forward effect of Fgf signaling on Foxg1-mediated cell cohesion. Thus, the mechanistic coupling and dynamic synchronization of tissue patterning with morphogenetic cell behavior through Fgf signaling leads to the graded allocation of cell positional identity in the eye, underlying retinotectal map formation. |
|
Tinevez JY, Schulze U, Salbreux G, Roensch J, Joanny JF, Paluch E
|
Role of cortical tension in bleb growth.
|
Proc. Natl. Acad. Sci. U.S.A. 2009 Nov 3;106(44):18581-6
|
|
Biophysics
|

|
19846787 |
|
Blebs are spherical membrane protrusions often observed during cell migration, cell spreading, cytokinesis, and apoptosis, both in cultured cells and in vivo. Bleb expansion is thought to be driven by the contractile actomyosin cortex, which generates hydrostatic pressure in the cytoplasm and can thus drive herniations of the plasma membrane. However, the role of cortical tension in bleb formation has not been directly tested, and despite the importance of blebbing, little is known about the mechanisms of bleb growth. In order to explore the link between cortical tension and bleb expansion, we induced bleb formation on cells with different tensions. Blebs were nucleated in a controlled manner by laser ablation of the cortex, mimicking endogenous bleb nucleation. Cortical tension was modified by treatments affecting the level of myosin activity or proteins regulating actin turnover. We show that there is a critical tension below which blebs cannot expand. Above this threshold, the maximal size of a bleb strongly depends on tension, and this dependence can be fitted with a model of the cortex as an active elastic material. Together, our observations and model allow us to relate bleb shape parameters to the underlying cellular mechanics and provide insights as to how bleb formation can be biochemically regulated during cell motility. |
|
Strilić B, Kucera T, Eglinger J, Hughes MR, McNagny KM, Tsukita S, Dejana E, Ferrara N, Lammert E
|
The molecular basis of vascular lumen formation in the developing mouse aorta.
|
Dev. Cell 2009 Oct;17(4):505-15
|
|
Developmental Biology
|

|
19853564 |
|
In vertebrates, endothelial cells (ECs) form blood vessels in every tissue. Here, we investigated vascular lumen formation in the developing aorta, the first and largest arterial blood vessel in all vertebrates. Comprehensive imaging, pharmacological manipulation, and genetic approaches reveal that, in mouse embryos, the aortic lumen develops extracellularly between adjacent ECs. We show that ECs adhere to each other, and that CD34-sialomucins, Moesin, F-actin, and non-muscle Myosin II localize at the endothelial cell-cell contact to define the luminal cell surface. Resultant changes in EC shape lead to lumen formation. Importantly, VE-Cadherin and VEGF-A act at different steps. VE-Cadherin is required for localizing CD34-sialomucins to the endothelial cell-cell contact, a prerequisite to Moesin and F-actin recruitment. In contrast, VEGF-A is required for F-actin-nm-Myosin II interactions and EC shape change. Based on these data, we propose a molecular mechanism of in vivo vascular lumen formation in developing blood vessels. |
|
Landsberg KP, Farhadifar R, Ranft J, Umetsu D, Widmann TJ, Bittig T, Said A, Jülicher F, Dahmann C
|
Increased cell bond tension governs cell sorting at the Drosophila anteroposterior compartment boundary.
|
Curr. Biol. 2009 Dec 1;19(22):1950-5
|
|
Developmental Biology
|

|
19879142 |
|
Subdividing proliferating tissues into compartments is an evolutionarily conserved strategy of animal development [1-6]. Signals across boundaries between compartments can result in local expression of secreted proteins organizing growth and patterning of tissues [1-6]. Sharp and straight interfaces between compartments are crucial for stabilizing the position of such organizers and therefore for precise implementation of body plans. Maintaining boundaries in proliferating tissues requires mechanisms to counteract cell rearrangements caused by cell division; however, the nature of such mechanisms remains unclear. Here we quantitatively analyzed cell morphology and the response to the laser ablation of cell bonds in the vicinity of the anteroposterior compartment boundary in developing Drosophila wings. We found that mechanical tension is approximately 2.5-fold increased on cell bonds along this compartment boundary as compared to the remaining tissue. Cell bond tension is decreased in the presence of Y-27632 [7], an inhibitor of Rho-kinase whose main effector is Myosin II [8]. Simulations using a vertex model [9] demonstrate that a 2.5-fold increase in local cell bond tension suffices to guide the rearrangement of cells after cell division to maintain compartment boundaries. Our results provide a physical mechanism in which the local increase in Myosin II-dependent cell bond tension directs cell sorting at compartment boundaries. |
|
Khaliullina H, Panáková D, Eugster C, Riedel F, Carvalho M, Eaton S
|
Patched regulates Smoothened trafficking using lipoprotein-derived lipids.
|
Development 2009 Dec 11;136(24):4111-21
|
|
Cell Biology
|

|
19906846 |
|
Hedgehog (Hh) is a lipoprotein-borne ligand that regulates both patterning and proliferation in a wide variety of vertebrate and invertebrate tissues. When Hh is absent, its receptor Patched (Ptc) represses Smoothened (Smo) signaling by an unknown catalytic mechanism that correlates with reduced Smo levels on the basolateral membrane. Ptc contains a sterol-sensing domain and is similar to the Niemann-Pick type C-1 protein, suggesting that Ptc might regulate lipid trafficking to repress Smo. However, no endogenous lipid regulators of Smo have yet been identified, nor has it ever been shown that Ptc actually controls lipid trafficking. Here, we show that Drosophila Ptc recruits internalized lipoproteins to Ptc-positive endosomes and that its sterol-sensing domain regulates trafficking of both lipids and Smo from this compartment. Ptc utilizes lipids derived from lipoproteins to destabilize Smo on the basolateral membrane. We propose that Ptc normally regulates Smo degradation by changing the lipid composition of endosomes through which Smo passes, and that the presence of Hh on lipoproteins inhibits utilization of their lipids by Ptc. |
|
Viktorinová I, König T, Schlichting K, Dahmann C
|
The cadherin Fat2 is required for planar cell polarity in the Drosophila ovary.
|
Development 2009 Dec 11;136(24):4123-32
|
|
Developmental Biology
|

|
19906848 |
|
Planar cell polarity is an important characteristic of many epithelia. In the Drosophila wing, eye and abdomen, establishment of planar cell polarity requires the core planar cell polarity genes and two cadherins, Fat and Dachsous. Drosophila Fat2 is a cadherin related to Fat; however, its role during planar cell polarity has not been studied. Here, we have generated mutations in fat2 and show that Fat2 is required for the planar polarity of actin filament orientation at the basal side of ovarian follicle cells. Defects in actin filament orientation correlate with a failure of egg chambers to elongate during oogenesis. Using a functional fosmid-based fat2-GFP transgene, we show that the distribution of Fat2 protein in follicle cells is planar polarized and that Fat2 localizes where basal actin filaments terminate. Mosaic analysis demonstrates that Fat2 acts non-autonomously in follicle cells, indicating that Fat2 is required for the transmission of polarity information. Our results suggest a principal role for Fat-like cadherins during the establishment of planar cell polarity. |
|
Cao X, Coskun U, Rössle M, Buschhorn SB, Grzybek M, Dafforn TR, Lenoir M, Overduin M, Simons K
|
Golgi protein FAPP2 tubulates membranes.
|
Proc. Natl. Acad. Sci. U.S.A. 2009 Dec 15;106(50):21121-5
|
|
Cell Biology
|

|
19940249 |
|
The Golgi-associated four-phosphate adaptor protein 2 (FAPP2) has been shown to possess transfer activity for glucosylceramide both in vitro and in cells. We have previously shown that FAPP2 is involved in apical transport from the Golgi complex in epithelial MDCK cells. In this paper we assign an unknown activity for the protein as well as providing structural insight into protein assembly and a low-resolution envelope structure. By applying analytical ultracentrifugation and small-angle x-ray scattering, we show that FAPP2 is a dimeric protein in solution, having a curved shape 30 nm in length. The purified FAPP2 protein has the capability to form tubules from membrane sheets in vitro. This activity is dependent on the phosphoinositide-binding activity of the PH domain of FAPP2. These data suggest that FAPP2 functions directly in the formation of apical carriers in the trans-Golgi network. |
|
Rein S, Hanisch U, Rammelt S, Schmidt G, Schaller HE, Zwipp H, Oehmke M, Weindel S
|
Histopathological, radiological and clinical aspects of the temporal assignment of scaphoid non-union.
|
Arch Orthop Trauma Surg 2010 Oct 01;130(10):1243-50
|
|
Medical Biology
|

|
19949806 |
|
The aim of this study was to evaluate the correlation between clinical, radiological and histopathological signs of scaphoid non-unions (SNU) with regard to the age of the fracture, primarily because this is relevant for therapy and compensation claims. |
|
Cardona A, Saalfeld S, Tomančák P, Hartenstein V
|
Drosophila brain development: closing the gap between a macroarchitectural and microarchitectural approach.
|
Cold Spring Harb. Symp. Quant. Biol. 2009 Dec 22;74:235-48
|
|
Developmental Biology
|

|
20028843 |
|
Neurobiologists address neural structure, development, and function at the level of "macrocircuits" (how different brain compartments are interconnected; what overall pattern of activity they produce) and at the level of "microcircuits" (how connectivity and physiology of individual neurons and their processes within a compartment determine the functional output of this compartment). Work in our lab aims at reconstructing the developing Drosophila brain at both levels. Macrocircuits can be approached conveniently by reconstructing the pattern of brain lineages, which form groups of neurons whose projections form cohesive fascicles interconnecting the compartments of the larval and adult brain. The reconstruction of microcircuits requires serial section electron microscopy, due to the small size of terminal neuronal processes and their synaptic contacts. Because of the amount of labor that traditionally comes with this approach, very little is known about microcircuitry in brains across the animal kingdom. Many of the problems of serial electron microscopy reconstruction are now solvable with digital image recording and specialized software for both image acquisition and postprocessing. In this chapter, we introduce our efforts to reconstruct the small Drosophila larval brain and discuss our results in light of the published data on neuropile ultrastructure in other animal taxa. |
|
Stiess M, Maghelli N, Kapitein LC, Gomis-Rüth S, Wilsch-Bräuninger M, Hoogenraad CC, Tolić-Nørrelykke IM, Bradke F
|
Axon extension occurs independently of centrosomal microtubule nucleation.
|
Science 2010 Feb 5;327(5966):704-7
|
|
Neurobiology
|

|
20056854 |
|
Microtubules are polymeric protein structures and components of the cytoskeleton. Their dynamic polymerization is important for diverse cellular functions. The centrosome is the classical site of microtubule nucleation and is thought to be essential for axon growth and neuronal differentiation--processes that require microtubule assembly. We found that the centrosome loses its function as a microtubule organizing center during development of rodent hippocampal neurons. Axons still extended and regenerated through acentrosomal microtubule nucleation, and axons continued to grow after laser ablation of the centrosome in early neuronal development. Thus, decentralized microtubule assembly enables axon extension and regeneration, and, after axon initiation, acentrosomal microtubule nucleation arranges the cytoskeleton, which is the source of the sophisticated morphology of neurons. |
|
Arboleda-Estudillo Y, Krieg M, Stühmer J, Licata NA, Muller DJ, Heisenberg CP
|
Movement directionality in collective migration of germ layer progenitors.
|
Curr. Biol. 2010 Jan 26;20(2):161-9
|
|
Cell Biology
|

|
20079641 |
|
Collective cell migration, the simultaneous movement of multiple cells that are connected by cell-cell adhesion, is ubiquitous in development, tissue repair, and tumor metastasis [1, 2]. It has been hypothesized that the directionality of cell movement during collective migration emerges as a collective property [3, 4]. Here we determine how movement directionality is established in collective mesendoderm migration during zebrafish gastrulation. By interfering with two key features of collective migration, (1) having neighboring cells and (2) adhering to them, we show that individual mesendoderm cells are capable of normal directed migration when moving as single cells but require cell-cell adhesion to participate in coordinated and directed migration when moving as part of a group. We conclude that movement directionality is not a de novo collective property of mesendoderm cells but rather a property of single mesendoderm cells that requires cell-cell adhesion during collective migration. |
|
Pan-Montojo F, Anichtchik O, Dening Y, Knels L, Pursche S, Jung R, Jackson S, Gille G, Spillantini MG, Reichmann H, Funk RH
|
Progression of Parkinson's disease pathology is reproduced by intragastric administration of rotenone in mice.
|
PLoS ONE 2010 Jan 19;5(1):e8762
|
|
Neurobiology
|

|
20098733 |
|
In patients with Parkinson's disease (PD), the associated pathology follows a characteristic pattern involving inter alia the enteric nervous system (ENS), the dorsal motor nucleus of the vagus (DMV), the intermediolateral nucleus of the spinal cord and the substantia nigra, providing the basis for the neuropathological staging of the disease. Here we report that intragastrically administered rotenone, a commonly used pesticide that inhibits Complex I of the mitochondrial respiratory chain, is able to reproduce PD pathological staging as found in patients. Our results show that low doses of chronically and intragastrically administered rotenone induce alpha-synuclein accumulation in all the above-mentioned nervous system structures of wild-type mice. Moreover, we also observed inflammation and alpha-synuclein phosphorylation in the ENS and DMV. HPLC analysis showed no rotenone levels in the systemic blood or the central nervous system (detection limit [rotenone]<20 nM) and mitochondrial Complex I measurements showed no systemic Complex I inhibition after 1.5 months of treatment. These alterations are sequential, appearing only in synaptically connected nervous structures, treatment time-dependent and accompanied by inflammatory signs and motor dysfunctions. These results strongly suggest that the local effect of pesticides on the ENS might be sufficient to induce PD-like progression and to reproduce the neuroanatomical and neurochemical features of PD staging. It provides new insight into how environmental factors could trigger PD and suggests a transsynaptic mechanism by which PD might spread throughout the central nervous system. |
|
Greenan G, Brangwynne CP, Jaensch S, Gharakhani J, Jülicher F, Hyman AA
|
Centrosome size sets mitotic spindle length in Caenorhabditis elegans embryos.
|
Curr. Biol. 2010 Feb 23;20(4):353-8
|
- LMF MPI-CBG
- LMF & EMF CFCI
|
Developmental Biology
|

|
20137951 |
|
Just as the size of an organism is carefully controlled, the size of intracellular structures must also be regulated. The mitotic spindle is a supramolecular machine that generates the forces which separate sister chromatids during mitosis. Although spindles show little size variation between cells of the same type, spindle length can vary at least 10-fold between different species. Recent experiments on spindle length showed that in embryonic systems spindle length varied with blastomere size. Furthermore, a comparison between two Xenopus species showed that spindle length was dependent on some cytoplasmic factor. These data point toward mechanisms to scale spindle length with cell size. Centrosomes play an important role in organizing microtubules during spindle assembly. Here we use Caenorhabditis elegans to study the role of centrosomes in setting spindle length. We show that spindle length correlates with centrosome size through development and that a reduction of centrosome size by molecular perturbation reduces spindle length. By systematically analyzing centrosome proteins, we show that spindle length does not depend on microtubule density at centrosomes. Rather, our data suggest that centrosome size sets mitotic spindle length by controlling the length scale of a TPXL-1 gradient along spindle microtubules. |
|
Peters N, Perez DE, Song MH, Liu Y, Müller-Reichert T, Caron C, Kemphues KJ, O'Connell KF
|
Control of mitotic and meiotic centriole duplication by the Plk4-related kinase ZYG-1.
|
J. Cell. Sci. 2010 Mar 1;123(Pt 5):795-805
|
|
Cell Biology
|

|
20144993 |
|
Centriole duplication is of crucial importance during both mitotic and male meiotic divisions, but it is currently not known whether this process is regulated differently during the two modes of division. In Caenorhabditis elegans, the kinase ZYG-1 plays an essential role in both mitotic and meiotic centriole duplication. We have found that the C-terminus of ZYG-1 is necessary and sufficient for targeting to centrosomes and is important for differentiating mitotic and meiotic centriole duplication. Small truncations of the C-terminus dramatically lower the level of ZYG-1 at mitotic centrosomes but have little effect on the level of ZYG-1 at meiotic centrosomes. Interestingly, truncation of ZYG-1 blocks centrosome duplication in the mitotic cycle but leads to centrosome amplification in the meiotic cycle. Meiotic centriole amplification appears to result from the overduplication of centrioles during meiosis I and leads to the formation of multipolar meiosis II spindles. The extra centrioles also disrupt spermatogenesis by inducing the formation of supernumerary fertilization-competent spermatids that contain abnormal numbers of chromosomes and centrioles. Our data reveal differences in the regulation of mitotic and meiotic centrosome duplication, particularly with regard to ZYG-1 activity, and reveal an important role for centrosomes in spermatid formation. |
|
Jing D, Fonseca AV, Alakel N, Fierro FA, Muller K, Bornhauser M, Ehninger G, Corbeil D, Ordemann R
|
Hematopoietic stem cells in co-culture with mesenchymal stromal cells--modeling the niche compartments in vitro.
|
Haematologica 2010 Apr 09;95(4):542-50
|
|
Medical Biology
|

|
20145267 |
|
Hematopoietic stem cells located in the bone marrow interact with a specific microenvironment referred to as the stem cell niche. Data derived from ex vivo co-culture systems using mesenchymal stromal cells as a feeder cell layer suggest that cell-to-cell contact has a significant impact on the expansion, migratory potential and 'stemness' of hematopoietic stem cells. Here we investigated in detail the spatial relationship between hematopoietic stem cells and mesenchymal stromal cells during ex vivo expansion. |
|
Shen J, Dahmann C, Pflugfelder GO
|
Spatial discontinuity of optomotor-blind expression in the Drosophila wing imaginal disc disrupts epithelial architecture and promotes cell sorting.
|
BMC Dev. Biol. 2010 Feb 23;10:23
|
|
Developmental Biology
|

|
20178599 |
|
Decapentaplegic (Dpp) is one of the best characterized morphogens, required for dorso-ventral patterning of the Drosophila embryo and for anterior-posterior (A/P) patterning of the wing imaginal disc. In the larval wing pouch, the Dpp target gene optomotor-blind (omb) is generally assumed to be expressed in a step function above a certain threshold of Dpp signaling activity. |
|
Kilic A, Klose S, Dobberstein B, Knust E, Kapp K
|
The Drosophila Crumbs signal peptide is unusually long and is a substrate for signal peptide peptidase.
|
Eur. J. Cell Biol. 2010 Jun 01;89(6):449-61
|
|
Cell Biology
|

|
20189678 |
|
N-terminal signal sequences mediate nascent protein targeting to and protein insertion into the membrane of the endoplasmic reticulum. They are typically 15-30 amino acid residues long with a core hydrophobic region flanked by an N-terminal (n-) and a C-terminal region. Following cleavage by signal peptidase, some of the resulting signal peptides are further processed by signal peptide peptidase (SPP) and fragments are liberated into the cytosol. Such fragments can have independent, post-targeting functions affecting diverse cellular processes. We show that Drosophila melanogaster Crumbs, a transmembrane protein controlling cell polarity and morphogenesis, is synthesized with an 83 residues-long signal sequence. To our knowledge, this is currently the longest signal sequence described for an eukaryotic protein. The unusual length is caused by an extended n-region, but the extension does neither affect protein targeting nor signal sequence cleavage. The signal sequence is cleaved off and the resulting signal peptide, SP(Crb), is proteolytically processed by SPP, thus representing the first substrate described for the Drosophila enzyme. We further show that signal peptide fragments can be degraded by the proteasome. Expression of transgenes encoding tagged variants of Crumbs in Drosophila embryos suggests that the signal peptide is short-lived in vivo. Our findings support a model suggesting that besides generating fragments with post-targeting functions, SPP-mediated processing is the first step in the degradation of signal peptides. |
|
Collinet C, Stöter M, Bradshaw CR, Samusik N, Rink JC, Kenski D, Habermann B, Buchholz F, Henschel R, Mueller MS, Nagel WE, Fava E, Kalaidzidis Y, Zerial M
|
Systems survey of endocytosis by multiparametric image analysis.
|
Nature 2010 Mar 11;464(7286):243-9
|
|
Image Processing
|

|
20190736 |
|
Endocytosis is a complex process fulfilling many cellular and developmental functions. Understanding how it is regulated and integrated with other cellular processes requires a comprehensive analysis of its molecular constituents and general design principles. Here, we developed a new strategy to phenotypically profile the human genome with respect to transferrin (TF) and epidermal growth factor (EGF) endocytosis by combining RNA interference, automated high-resolution confocal microscopy, quantitative multiparametric image analysis and high-performance computing. We identified several novel components of endocytic trafficking, including genes implicated in human diseases. We found that signalling pathways such as Wnt, integrin/cell adhesion, transforming growth factor (TGF)-beta and Notch regulate the endocytic system, and identified new genes involved in cargo sorting to a subset of signalling endosomes. A systems analysis by Bayesian networks further showed that the number, size, concentration of cargo and intracellular position of endosomes are not determined randomly but are subject to specific regulation, thus uncovering novel properties of the endocytic system. |
|
Walter T, Shattuck DW, Baldock R, Bastin ME, Carpenter AE, Duce S, Ellenberg J, Fraser A, Hamilton N, Pieper S, Ragan MA, Schneider JE, Tomancak P, Hériché JK
|
Visualization of image data from cells to organisms.
|
Nat. Methods 2010 Mar;7(3 Suppl):S26-41
|
|
Image Processing
|

|
20195255 |
|
Advances in imaging techniques and high-throughput technologies are providing scientists with unprecedented possibilities to visualize internal structures of cells, organs and organisms and to collect systematic image data characterizing genes and proteins on a large scale. To make the best use of these increasingly complex and large image data resources, the scientific community must be provided with methods to query, analyze and crosslink these resources to give an intuitive visual representation of the data. This review gives an overview of existing methods and tools for this purpose and highlights some of their limitations and challenges. |
|
Anitei M, Stange C, Parshina I, Baust T, Schenck A, Raposo G, Kirchhausen T, Hoflack B
|
Protein complexes containing CYFIP/Sra/PIR121 coordinate Arf1 and Rac1 signalling during clathrin-AP-1-coated carrier biogenesis at the TGN.
|
Nat. Cell Biol. 2010 Apr 14;12(4):330-40
|
|
Cell Biology
|

|
20228810 |
|
Actin dynamics is a tightly regulated process involved in various cellular events including biogenesis of clathrin-coated, AP-1 (adaptor protein 1)-coated transport carriers connecting the trans-Golgi network (TGN) and the endocytic pathway. However, the mechanisms coordinating coat assembly, membrane and actin remodelling during post-TGN transport remain poorly understood. Here we show that the Arf1 (ADP-ribosylation factor 1) GTPase synchronizes the TGN association of clathrin-AP-1 coats and protein complexes comprising CYFIP (cytoplasmic fragile-X mental retardation interacting protein; Sra, PIR121), a clathrin heavy chain binding protein associated with mental retardation. The Rac1 GTPase and its exchange factor beta-PIX (PAK-interacting exchange factor) activate these complexes, allowing N-WASP-dependent and Arp2/3-dependent actin polymerization towards membranes, thus promoting tubule formation. These phenomena can be recapitulated with synthetic membranes. This protein-network-based mechanism facilitates the sequential coordination of Arf1-dependent membrane priming, through the recruitment of coats and CYFIP-containing complexes, and of Rac1-dependent actin polymerization, and provides complementary but independent levels of regulation during early stages of clathrin-AP1-coated carrier biogenesis. |
|
Katis VL, Lipp JJ, Imre R, Bogdanova A, Okaz E, Habermann B, Mechtler K, Nasmyth K, Zachariae W
|
Rec8 phosphorylation by casein kinase 1 and Cdc7-Dbf4 kinase regulates cohesin cleavage by separase during meiosis.
|
Dev. Cell 2010 Mar 16;18(3):397-409
|
|
Cell Biology
|

|
20230747 |
|
During meiosis, two rounds of chromosome segregation after a single round of DNA replication produce haploid gametes from diploid precursors. At meiosis I, maternal and paternal kinetochores are pulled toward opposite poles, and chiasmata holding bivalent chromosomes together are resolved by cleavage of cohesin's alpha-kleisin subunit (Rec8) along chromosome arms. This creates dyad chromosomes containing a pair of chromatids joined solely by cohesin at centromeres that had resisted cleavage. The discovery that centromeric Rec8 is protected from separase during meiosis I by shugoshin/MEI-S332 proteins that bind PP2A phosphatase suggests that phosphorylation either of separase or cohesin may be necessary for Rec8 cleavage. We show here that multiple phosphorylation sites within Rec8 as well as two different kinases, casein kinase 1delta/epsilon (CK1delta/epsilon) and Dbf4-dependent Cdc7 kinase (DDK), are required for Rec8 cleavage and meiosis I nuclear division. Rec8 with phosphomimetic mutations is no longer protected from separase at centromeres and is cleaved even when the two kinases are inhibited. Our data suggest that PP2A protects centromeric cohesion by opposing CK1delta/epsilon- and DDK-dependent phosphorylation of Rec8. |
|
Jászai J, Farkas LM, Fargeas CA, Janich P, Haase M, Huttner WB, Corbeil D
|
Prominin-2 is a novel marker of distal tubules and collecting ducts of the human and murine kidney.
|
Histochem. Cell Biol. 2010 May 24;133(5):527-39
|
|
Cell Biology
|

|
20333396 |
|
Prominin-1 (CD133) and its paralogue, prominin-2, are pentaspan membrane glycoproteins that are strongly expressed in the kidney where they have been originally cloned from. Previously, we have described the localization of prominin-1 in proximal tubules of the nephron. The spatial distribution of prominin-2, however, has not yet been documented in the kidney. We therefore examined the expression of this molecule along distinct tubular segments of the human and murine nephron using in situ hybridization and immunohistochemistry. Our findings indicated that human prominin-2 transcripts and protein were confined to distal tubules of the nephron including the thick ascending limb of Henle's loop and the distal convoluted tubule, the connecting duct and to the collecting duct system. Therein, this glycoprotein was enriched at the basolateral plasma membrane of the tubular epithelial cells with exception of the thick ascending limb where it was also found in the apical domain. This is in contrast with the exclusive apical localization of prominin-1 in epithelial cells of proximal nephron tubules. The distribution of murine prominin-2 transcripts was reminiscent of its human orthologue. In addition, a marked enrichment in the epithelium covering the papilla and in the urothelium of the renal pelvis was noted in mice. Finally, our biochemical analysis revealed that prominin-2 was released into the clinically healthy human urine as a constituent of small membrane vesicles. Collectively our data show the distribution and subcellular localization of prominin-2 within the kidney in situ and its release into the urine. Urinary detection of this protein might offer novel diagnostic approaches for studying renal diseases affecting distal segments of the nephron. |
|
Müller-Reichert T, Greenan G, O'Toole E, Srayko M
|
The elegans of spindle assembly.
|
Cell. Mol. Life Sci. 2010 Jul 26;67(13):2195-213
|
|
Cell Biology
|

|
20339898 |
|
The Caenorhabditis elegans one-cell embryo is a powerful system in which to study microtubule organization because this large cell assembles both meiotic and mitotic spindles within the same cytoplasm over the course of 1 h in a stereotypical manner. The fertilized oocyte assembles two consecutive acentrosomal meiotic spindles that function to reduce the replicated maternal diploid set of chromosomes to a single-copy haploid set. The resulting maternal DNA then unites with the paternal DNA to form a zygotic diploid complement, around which a centrosome-based mitotic spindle forms. The early C. elegans embryo is amenable to live-cell imaging and electron tomography, permitting a detailed structural comparison of the meiotic and mitotic modes of spindle assembly. |
|
Strzelecka M, Trowitzsch S, Weber G, Lührmann R, Oates AC, Neugebauer KM
|
Coilin-dependent snRNP assembly is essential for zebrafish embryogenesis.
|
Nat. Struct. Mol. Biol. 2010 Apr 28;17(4):403-9
|
|
Developmental Biology
|

|
20357773 |
|
Spliceosomal small nuclear ribonucleoproteins (snRNPs), comprised of small nuclear RNAs (snRNAs) in complex with snRNP-specific proteins, are essential for pre-mRNA splicing. Coilin is not a snRNP protein but concentrates snRNPs and their assembly intermediates in Cajal bodies (CBs). Here we show that depletion of coilin in zebrafish embryos leads to CB dispersal, deficits in snRNP biogenesis and expression of spliced mRNA, as well as reduced cell proliferation followed by developmental arrest. Notably, injection of purified mature human snRNPs restored mRNA expression and viability. snRNAs were necessary but not sufficient for rescue, showing that only assembled snRNPs can bypass the requirement for coilin. Thus, coilin's essential function in embryos is to promote macromolecular assembly of snRNPs, likely by concentrating snRNP components in CBs to overcome rate-limiting assembly steps. |
|
Hutchins JR, Toyoda Y, Hegemann B, Poser I, Hériché JK, Sykora MM, Augsburg M, Hudecz O, Buschhorn BA, Bulkescher J, Conrad C, Comartin D, Schleiffer A, Sarov M, Pozniakovsky A, Slabicki MM, Schloissnig S, Steinmacher I, Leuschner M, Ssykor A, Lawo S, Pelletier L, Stark H, Nasmyth K, Ellenberg J, Durbin R, Buchholz F, Mechtler K, Hyman AA, Peters JM
|
Systematic analysis of human protein complexes identifies chromosome segregation proteins.
|
Science 2010 Apr 30;328(5978):593-9
|
|
Cell Biology
|

|
20360068 |
|
Chromosome segregation and cell division are essential, highly ordered processes that depend on numerous protein complexes. Results from recent RNA interference screens indicate that the identity and composition of these protein complexes is incompletely understood. Using gene tagging on bacterial artificial chromosomes, protein localization, and tandem-affinity purification-mass spectrometry, the MitoCheck consortium has analyzed about 100 human protein complexes, many of which had not or had only incompletely been characterized. This work has led to the discovery of previously unknown, evolutionarily conserved subunits of the anaphase-promoting complex and the gamma-tubulin ring complex--large complexes that are essential for spindle assembly and chromosome segregation. The approaches we describe here are generally applicable to high-throughput follow-up analyses of phenotypic screens in mammalian cells. |
|
Schenk C, Bringmann H, Hyman AA, Cowan CR
|
Cortical domain correction repositions the polarity boundary to match the cytokinesis furrow in C. elegans embryos.
|
Development 2010 May;137(10):1743-53
|
|
Developmental Biology
|

|
20430749 |
|
In asymmetrically dividing cells, a failure to coordinate cell polarity with the site of cell division can lead to cell fate transformations and tumorigenesis. Cell polarity in C. elegans embryos is defined by PAR proteins, which occupy reciprocal halves of the cell cortex. During asymmetric division, the boundary between the anterior and posterior PAR domains precisely matches the site of cell division, ensuring exclusive segregation of cell fate. The PAR domains determine the site of cell division by positioning the mitotic spindle, suggesting one means by which cell polarity and cell division might be coordinated. Here, we report that cell polarity and cell division are coordinated through an additional mechanism: the site of cell division repositions the PAR-2 boundary. Galpha-mediated microtubule-cortex interactions appear to direct cortical flows of PAR-2 and myosin toward the site of cell division, which acts as a PAR-2 and myosin sink. Embryos with defects in PAR-2 boundary correction undergo mis-segregation of cortical polarity and cytoplasmic determinants, suggesting that PAR domain correction might help prevent cell fate transformation. |
|
Gloor Y, Schöne M, Habermann B, Ercan E, Beck M, Weselek G, Müller-Reichert T, Walch-Solimena C
|
Interaction between Sec7p and Pik1p: the first clue for the regulation of a coincidence detection signal.
|
Eur. J. Cell Biol. 2010 Aug;89(8):575-83
|
- LMF MPI-CBG
- LMF & EMF CFCI
|
Cell Biology
|

|
20434792 |
|
Sec7p, a guanine nucleotide exchange factor, regulates the activation of small Arf GTPases, which function in the formation of distinct classes of transport carriers from the Golgi. The recruitment of a subset of Arf effectors depends on the cooperation between these GTPases and phosphatidylinositol 4-phosphate. Here, we show that the catalytic domain of Sec7p interacts with a conserved region of the Golgi phosphatidylinositol 4-kinase Pik1p. We found that Sec7p and Pik1p as well as its product, colocalize at the late Golgi. Gea1p/Gea2p, an alternative pair of Arf activators, do not bind to Pik1p and function on a different Golgi sub-compartment. Sec7p and Pik1p interact with each other and cooperate in the formation of clathrin-coated vesicles. This interaction reveals a distinct role for Sec7p among the Golgi Arf-GEFs and provides a working model for the coordinated generation of Arf-GTP and phosphatiylinositol 4-phosphate as dual signal for specific recruitment of clathrin coats to the late Golgi. |
|
Poteryaev D, Datta S, Ackema K, Zerial M, Spang A
|
Identification of the switch in early-to-late endosome transition.
|
Cell 2010 Apr 30;141(3):497-508
|
|
Developmental Biology
|

|
20434987 |
|
Sequential transport from early to late endosomes requires the coordinated activities of the small GTPases Rab5 and Rab7. The transition between early and late endosomes could be mediated either through transport carriers or by Rab conversion, a process in which the loss of Rab5 from an endosome occurs concomitantly to the acquisition of Rab7. We demonstrate that Rab conversion is the mechanism by which proteins pass from early to late endosomes in Caenorhabditis elegans coelomocytes. Moreover, we identified SAND-1/Mon1 as the critical switch for Rab conversion in metazoa. SAND-1 serves a dual role in this process. First, it interrupts the positive feedback loop of RAB-5 activation by displacing RABX-5 from endosomal membranes; second, it times the recruitment of RAB-7, probably through interaction with the HOPS complex to the same membranes. SAND-1/Mon1 thus acts as a switch by controlling the localization of RAB-5 and RAB-7 GEFs. |
|
Fietz SA, Kelava I, Vogt J, Wilsch-Bräuninger M, Stenzel D, Fish JL, Corbeil D, Riehn A, Distler W, Nitsch R, Huttner WB
|
OSVZ progenitors of human and ferret neocortex are epithelial-like and expand by integrin signaling.
|
Nat. Neurosci. 2010 Jun 02;13(6):690-9
|
|
Neurobiology
|

|
20436478 |
|
A major cause of the cerebral cortex expansion that occurred during evolution is the increase in subventricular zone (SVZ) progenitors. We found that progenitors in the outer SVZ (OSVZ) of developing human neocortex retain features of radial glia, in contrast to rodent SVZ progenitors, which have limited proliferation potential. Although delaminating from apical adherens junctions, OSVZ progenitors maintained a basal process contacting the basal lamina, a canonical epithelial property. OSVZ progenitor divisions resulted in asymmetric inheritance of their basal process. Notably, OSVZ progenitors are also found in the ferret, a gyrencephalic nonprimate. Functional disruption of integrins, expressed on the basal process of ferret OSVZ progenitors, markedly decreased the OSVZ progenitor population size, but not that of other, process-lacking SVZ progenitors, in slice cultures of ferret neocortex. Our findings suggest that maintenance of this epithelial property allows integrin-mediated, repeated asymmetric divisions of OSVZ progenitors, providing a basis for neocortical expansion. |
|
Akinc A, Querbes W, De S, Qin J, Frank-Kamenetsky M, Jayaprakash KN, Jayaraman M, Rajeev KG, Cantley WL, Dorkin JR, Butler JS, Qin L, Racie T, Sprague A, Fava E, Zeigerer A, Hope MJ, Zerial M, Sah DW, Fitzgerald K, Tracy MA, Manoharan M, Koteliansky V, Fougerolles Ad, Maier MA
|
Targeted delivery of RNAi therapeutics with endogenous and exogenous ligand-based mechanisms.
|
Mol. Ther. 2010 Jul 11;18(7):1357-64
|
|
Imaging Technologies Development
|

|
20461061 |
|
Lipid nanoparticles (LNPs) have proven to be highly efficient carriers of short-interfering RNAs (siRNAs) to hepatocytes in vivo; however, the precise mechanism by which this efficient delivery occurs has yet to be elucidated. We found that apolipoprotein E (apoE), which plays a major role in the clearance and hepatocellular uptake of physiological lipoproteins, also acts as an endogenous targeting ligand for ionizable LNPs (iLNPs), but not cationic LNPs (cLNPs). The role of apoE was investigated using both in vitro studies employing recombinant apoE and in vivo studies in wild-type and apoE(-/-) mice. Receptor dependence was explored in vitro and in vivo using low-density lipoprotein receptor (LDLR(-/-))-deficient mice. As an alternative to endogenous apoE-based targeting, we developed a targeting approach using an exogenous ligand containing a multivalent N-acetylgalactosamine (GalNAc)-cluster, which binds with high affinity to the asialoglycoprotein receptor (ASGPR) expressed on hepatocytes. Both apoE-based endogenous and GalNAc-based exogenous targeting appear to be highly effective strategies for the delivery of iLNPs to liver. |
|
Stirnnagel K, Lüftenegger D, Stange A, Swiersy A, Müllers E, Reh J, Stanke N, Grosse A, Chiantia S, Keller H, Schwille P, Hanenberg H, Zentgraf H, Lindemann D
|
Analysis of prototype foamy virus particle-host cell interaction with autofluorescent retroviral particles.
|
Retrovirology 2010 May 17;7:45
|
|
Medical Biology
|

|
20478027 |
|
The foamy virus (FV) replication cycle displays several unique features, which set them apart from orthoretroviruses. First, like other B/D type orthoretroviruses, FV capsids preassemble at the centrosome, but more similar to hepadnaviruses, FV budding is strictly dependent on cognate viral glycoprotein coexpression. Second, the unusually broad host range of FV is thought to be due to use of a very common entry receptor present on host cell plasma membranes, because all cell lines tested in vitro so far are permissive. |
|
Kranz A, Fu J, Duerschke K, Weidlich S, Naumann R, Stewart AF, Anastassiadis K
|
An improved Flp deleter mouse in C57Bl/6 based on Flpo recombinase.
|
Genesis 2010 Aug;48(8):512-20
|
|
Imaging Technologies Development
|

|
20506501 |
|
Recently, a codon improved version of the Flpe site specific recombinase, termed Flpo, was reported as having greatly improved performance in mammalian cell applications. However, the degree of improvement could not be estimated because essentially no Flpe activity was observed. Here, we compare Flpe and Flpo accurately in a mammalian cell assay to estimate that Flpo is about five times more active than Flpe and similar to Cre and Dre. Consequently, we generated a Flpo deleter mouse line from the JM8 C57Bl/6 ES cells used in the EUCOMM and KOMP systematic knock-out programs. In breeding experiments, we show that the Flpo deleter delivers complete recombination using alleles that are incompletely recombined by a commonly used Flpe deleter. This indicates that the Flpo deleter is more efficient. |
|
Preibisch S, Saalfeld S, Schindelin J, Tomančák P
|
Software for bead-based registration of selective plane illumination microscopy data.
|
Nat. Methods 2010 Jun;7(6):418-9
|
|
Image Processing
|

|
20508634 |
|
|
|
Schroth-Diez B, Gerwig S, Ecke M, Hegerl R, Diez S, Gerisch G
|
Propagating waves separate two states of actin organization in living cells.
|
HFSP J 2009 Dec 30;3(6):412-27
|
|
Biophysics
|

|
20514132 |
|
Propagating actin waves are dynamic supramolecular structures formed by the self-assembly of proteins within living cells. They are built from actin filaments together with single-headed myosin, the Arp23 complex, and coronin in a defined three-dimensional order. The function of these waves in structuring the cell cortex is studied on the substrate-attached surface of Dictyostelium cells by the use of total internal reflection fluorescence (TIRF) microscopy. Actin waves separate two areas of the cell cortex from each other, which are distinguished by the arrangement of actin filaments. The Arp23 complex dominates in the area enclosed by a wave, where it has the capacity of building dendritic structures, while the proteins prevailing in the external area, cortexillin I and myosin-II, bundle actin filaments and arrange them in antiparallel direction. Wave propagation is accompanied by transitions in the state of actin with a preferential period of 5 min. Wave generation is preceded by local fluctuations in actin assembly, some of the nuclei of polymerized actin emanating from clathrin-coated structures, others emerging independently. The dynamics of phase transitions has been analyzed to provide a basis for modeling the nonlinear interactions that produce spatio-temporal patterns in the actin system of living cells. |
|
Jaensch S, Decker M, Hyman AA, Myers EW
|
Automated tracking and analysis of centrosomes in early Caenorhabditis elegans embryos.
|
Bioinformatics 2010 Jun 15;26(12):i13-20
|
|
Image Processing
|

|
20529897 |
|
The centrosome is a dynamic structure in animal cells that serves as a microtubule organizing center during mitosis and also regulates cell-cycle progression and sets polarity cues. Automated and reliable tracking of centrosomes is essential for genetic screens that study the process of centrosome assembly and maturation in the nematode Caenorhabditis elegans. |
|
Saalfeld S, Cardona A, Hartenstein V, Tomančák P
|
As-rigid-as-possible mosaicking and serial section registration of large ssTEM datasets.
|
Bioinformatics 2010 Jun 15;26(12):i57-63
|
|
Image Processing
|

|
20529937 |
|
Tiled serial section Transmission Electron Microscopy (ssTEM) is increasingly used to describe high-resolution anatomy of large biological specimens. In particular in neurobiology, TEM is indispensable for analysis of synaptic connectivity in the brain. Registration of ssTEM image mosaics has to recover the 3D continuity and geometrical properties of the specimen in presence of various distortions that are applied to the tissue during sectioning, staining and imaging. These include staining artifacts, mechanical deformation, missing sections and the fact that structures may appear dissimilar in consecutive sections. |
|
Mottola G, Classen AK, González-Gaitán M, Eaton S, Zerial M
|
A novel function for the Rab5 effector Rabenosyn-5 in planar cell polarity.
|
Development 2010 Jul 09;137(14):2353-64
|
|
Developmental Biology
|

|
20534670 |
|
In addition to apicobasal polarization, some epithelia also display polarity within the plane of the epithelium. To what extent polarized endocytosis plays a role in the establishment and maintenance of planar cell polarity (PCP) is at present unclear. Here, we investigated the role of Rabenosyn-5 (Rbsn-5), an evolutionarily conserved effector of the small GTPase Rab5, in the development of Drosophila wing epithelium. We found that Rbsn-5 regulates endocytosis at the apical side of the wing epithelium and, surprisingly, further uncovered a novel function of this protein in PCP. At early stages of pupal wing development, the PCP protein Fmi redistributes between the cortex and Rab5- and Rbsn-5-positive early endosomes. During planar polarization, Rbsn-5 is recruited at the apical cell boundaries and redistributes along the proximodistal axis in an Fmi-dependent manner. At pre-hair formation, Rbsn-5 accumulates at the bottom of emerging hairs. Loss of Rbsn-5 causes intracellular accumulation of Fmi and typical PCP alterations such as defects in cell packing, in the polarized distribution of PCP proteins, and in hair orientation and formation. Our results suggest that establishment of planar polarity requires the activity of Rbsn-5 in regulating both the endocytic trafficking of Fmi at the apical cell boundaries and hair morphology. |
|
Farhan H, Wendeler MW, Mitrovic S, Fava E, Silberberg Y, Sharan R, Zerial M, Hauri HP
|
MAPK signaling to the early secretory pathway revealed by kinase/phosphatase functional screening.
|
J. Cell Biol. 2010 Jun 14;189(6):997-1011
|
|
Cell Biology
|

|
20548102 |
|
To what extent the secretory pathway is regulated by cellular signaling is unknown. In this study, we used RNA interference to explore the function of human kinases and phosphatases in controlling the organization of and trafficking within the secretory pathway. We identified 122 kinases/phosphatases that affect endoplasmic reticulum (ER) export, ER exit sites (ERESs), and/or the Golgi apparatus. Numerous kinases/phosphatases regulate the number of ERESs and ER to Golgi protein trafficking. Among the pathways identified, the Raf-MEK (MAPK/ERK [extracellular signal-regulated kinase] kinase)-ERK cascade, including its regulatory proteins CNK1 (connector enhancer of the kinase suppressor of Ras-1) and neurofibromin, controls the number of ERESs via ERK2, which targets Sec16, a key regulator of ERESs and COPII (coat protein II) vesicle biogenesis. Our analysis reveals an unanticipated complexity of kinase/phosphatase-mediated regulation of the secretory pathway, uncovering a link between growth factor signaling and ER export. |
|
Ozkucur N, Epperlein HH, Funk RH
|
Ion imaging during axolotl tail regeneration in vivo.
|
Dev. Dyn. 2010 Jul;239(7):2048-57
|
|
Developmental Biology
|

|
20549718 |
|
Several studies have reported that endogenous ion currents are involved in a wide range of biological processes from single cell and tissue behavior to regeneration. Various methods are used to assess intracellular and local ion dynamics in biological systems, e.g., patch clamping and vibrating probes. Here, we introduce an approach to detect ion kinetics in vivo using a noninvasive method that can electrophysiologically characterize an entire experimental tissue region or organism. Ion-specific vital dyes have been successfully used for live imaging of intracellular ion dynamics in vitro. Here, we demonstrate that cellular pH, cell membrane potential, calcium, sodium and potassium can be monitored in vivo during tail regeneration in the axolotl (Ambystoma mexicanum) using ion-specific vital dyes. Thus, we suggest that ion-specific vital dyes can be a powerful tool to obtain electrophysiological data during crucial biological events in vivo. |
|
Bickle M
|
The beautiful cell: high-content screening in drug discovery.
|
Anal Bioanal Chem 2010 Sep 25;398(1):219-26
|
|
Imaging Technologies Development
|
|
20577725 |
|
The term "high-content screening" has become synonymous with imaging screens using automated microscopes and automated image analysis. The term was coined a little over 10 years ago. Since then the technology has evolved considerably and has established itself firmly in the drug discovery and development industry. Both the instruments and the software controlling the instruments and analyzing the data have come to maturity, so the full benefits of high-content screening can now be realized. Those benefits are the capability of carrying out phenotypic multiparametric cellular assays in an unbiased, fully automated, and quantitative fashion. Automated microscopes and automated image analysis are being applied at all stages of the drug discovery and development pipeline. All major pharmaceutical companies have adopted the technology and it is in the process of being embraced broadly by the academic community. This review aims at describing the current capabilities and limits of the technology as well as highlighting necessary developments that are required to exploit fully the potential of high-content screening and analysis. |
|
Hoege C, Constantinescu AT, Schwager A, Goehring NW, Kumar P, Hyman AA
|
LGL can partition the cortex of one-cell Caenorhabditis elegans embryos into two domains.
|
Curr. Biol. 2010 Jul 27;20(14):1296-303
|
|
Cell Biology
|

|
20579886 |
|
Many metazoan cell types are polarized by asymmetric partitioning of the conserved PAR (PAR-3/PAR-6/PKC-3) complex. Cortical domains containing this PAR complex are counterbalanced by opposing domains of varying composition. The tumor-suppressor protein LGL facilitates asymmetric localization of cell fate determinants, in part through modulating the activity of the PAR complex. However, the mechanisms by which LGL acts to maintain a cortical domain remain unclear. Here we identify Caenorhabditis elegans LGL in a biochemical complex with PAR proteins, which localize to the anterior cortex. But LGL itself localizes to the posterior cortex. We show that increasing the amounts of LGL can restrict localization of the PAR complex to an anterior cortical domain, even in the absence of PAR-2. Importantly, LGL must be phosphorylated on conserved residues to exert this function. LGL and the PAR complex can maintain two cortical domains that are sufficient to partition cell fate determinants. Our data suggest a mechanism of "mutual elimination" in which an LGL phosphorylation cycle regulates association of the PAR complex with the cortex: binding of LGL to the PAR complex at the interface of the two domains stimulates its phosphorylation by PKC-3, and the whole complex leaves the cortex. |
|
Kupinski AP, Müller-Reichert T, Eckmann CR
|
The Caenorhabditis elegans Ste20 kinase, GCK-3, is essential for postembryonic developmental timing and regulates meiotic chromosome segregation.
|
Dev. Biol. 2010 Aug 15;344(2):758-71
|
- EMF MPI-CBG
- LMF MPI-CBG
- LMF & EMF CFCI
|
Developmental Biology
|

|
20595048 |
|
Ste20 kinases constitute a large family of serine/threonine kinases with a plethora of biological functions. Members of the GCK-VI subfamily have been identified as important regulators of osmohomeostasis across species functioning upstream of ion channels. Although the expression of the two highly similar mammalian GCK-VI kinases is eminent in a wide variety of tissues, which includes also the testis, their potential roles in development remain elusive. Caenorhabditis elegans contains a single ancestral ortholog termed GCK-3. Here, we report a comprehensive analysis of gck-3 function and demonstrate its requirement for several developmental processes independent of ion homeostasis, i.e., larval progression, vulva, and germ line formation. Consistent with a wide range of gck-3 function we find that endogenous GCK-3 is expressed ubiquitously. The serine/threonine kinase activity of GCK-3, but not its presumed C-terminal substrate interaction domain, is essential for gck-3 gene function. Although expressed in female germ cells, we find GCK-3 progressively accumulating during spermatogenesis where it promotes the first meiotic cell division and facilitates faithful chromosome segregation. In particular, we find that different levels of gck-3 activity appear to be important for various aspects of germ line development. Taken together, our findings suggest that members of the GCK-VI kinase subfamily may act as key regulators of many developmental processes and that this newly described role in meiotic progression might be conserved and an important part of sexual reproduction. |
|
Ganz J, Kaslin J, Hochmann S, Freudenreich D, Brand M
|
Heterogeneity and Fgf dependence of adult neural progenitors in the zebrafish telencephalon.
|
Glia 2010 Aug 15;58(11):1345-63
|
|
Neurobiology
|

|
20607866 |
|
Adult telencephalic neurogenesis is a conserved trait of all vertebrates studied. It has been investigated in detail in rodents, but very little is known about the composition of neurogenic niches and the cellular nature of progenitors in nonmammalian vertebrates. To understand the components of the progenitor zones in the adult zebrafish telencephalon and the link between glial characteristics and progenitor state, we examined whether canonical glial markers are colocalized with proliferation markers. In the adult zebrafish telencephalon, we identify heterogeneous progenitors that reside in two distinct glial domains. We find that the glial composition of the progenitor zone is linked to its proliferative behavior. Analyzing both fast-cycling proliferating cells as well as slowly cycling progenitors, we find four distinct progenitor types characterized by differential expression of glial markers. Importantly, a significant proportion of progenitors do not display typical radial glia characteristics. By blocking or activating Fgf signaling by misexpression of a dominant negative Fgf-receptor 1 or Fgf8a, respectively, we find that ventral and dorsal progenitors in the telencephalon also differ in their requirement for Fgf signaling. Together with data on the expression of Fgf signaling components in the ventricular zone of the telencephalon, this suggests that Fgf signaling directly regulates proliferation of specific subsets of adult telencephalic progenitors in vivo. Taken together our results show that adult neural progenitor cells are heterogeneous with their respect to distribution into two distinct glial domains and their dependence upon Fgf signaling as a proliferative cue in the zebrafish telencephalon. |
|
Slabicki M, Theis M, Krastev DB, Samsonov S, Mundwiller E, Junqueira M, Paszkowski-Rogacz M, Teyra J, Heninger AK, Poser I, Prieur F, Truchetto J, Confavreux C, Marelli C, Durr A, Camdessanche JP, Brice A, Shevchenko A, Pisabarro MT, Stevanin G, Buchholz F
|
A genome-scale DNA repair RNAi screen identifies SPG48 as a novel gene associated with hereditary spastic paraplegia.
|
PLoS Biol. 2010 Jun 29;8(6):e1000408
|
|
Cell Biology
|

|
20613862 |
|
DNA repair is essential to maintain genome integrity, and genes with roles in DNA repair are frequently mutated in a variety of human diseases. Repair via homologous recombination typically restores the original DNA sequence without introducing mutations, and a number of genes that are required for homologous recombination DNA double-strand break repair (HR-DSBR) have been identified. However, a systematic analysis of this important DNA repair pathway in mammalian cells has not been reported. Here, we describe a genome-scale endoribonuclease-prepared short interfering RNA (esiRNA) screen for genes involved in DNA double strand break repair. We report 61 genes that influenced the frequency of HR-DSBR and characterize in detail one of the genes that decreased the frequency of HR-DSBR. We show that the gene KIAA0415 encodes a putative helicase that interacts with SPG11 and SPG15, two proteins mutated in hereditary spastic paraplegia (HSP). We identify mutations in HSP patients, discovering KIAA0415/SPG48 as a novel HSP-associated gene, and show that a KIAA0415/SPG48 mutant cell line is more sensitive to DNA damaging drugs. We present the first genome-scale survey of HR-DSBR in mammalian cells providing a dataset that should accelerate the discovery of novel genes with roles in DNA repair and associated medical conditions. The discovery that proteins forming a novel protein complex are required for efficient HR-DSBR and are mutated in patients suffering from HSP suggests a link between HSP and DNA repair. |
|
Ludwig B, Ziegler CG, Schally AV, Richter C, Steffen A, Jabs N, Funk RH, Brendel MD, Block NL, Ehrhart-Bornstein M, Bornstein SR
|
Agonist of growth hormone-releasing hormone as a potential effector for survival and proliferation of pancreatic islets.
|
Proc. Natl. Acad. Sci. U.S.A. 2010 Jul 13;107(28):12623-8
|
|
Medical Biology
|

|
20616039 |
|
Therapeutic strategies for transplantation of pancreatic islet cells are urgently needed to expand beta-cell mass by stimulating islet cell proliferation and/or prolonging islet cell survival. Control of the islets by different growth factors provides a potential venue for augmenting beta-cell mass. In the present study, we show the expression of the biologically active splice variant-1 (SV-1) of growth hormone-releasing hormone (GHRH) receptor in rat insulinoma (INS-1) cells as well as in rat and human pancreatic islets. In studies in vitro of INS-1 cells, the GHRH agonist JI-36 caused a significant increase in cell proliferation and a reduction of cell apoptosis. JI-36 increased islet size and glucose-stimulated insulin secretion in isolated rat islets after 48-72 h. At the ultrastructural level, INS-1 cells treated with agonist JI-36 revealed a metabolic active stimulation state with increased cytoplasm. Coincubation with the GHRH antagonist MIA-602 reversed the actions of the agonist JI-36, indicating the specificity of this agonist. In vivo, the function of pancreatic islets was assessed by transplantation of rat islets under the kidney capsule of streptozotocin-induced diabetic non-obese diabetic-severe combined immunodeficiency (NOD-SCID) mice. Islets treated with GHRH agonist JI-36 were able to achieve normoglycemia earlier and more consistently than untreated islets. Furthermore, in contrast to diabetic animals transplanted with untreated islets, insulin response to an i.p. glucose tolerance test (IPGTT) in animals receiving islets treated with agonist Jl-36 was comparable to that of normal healthy mice. In conclusion, our study provides evidence that agonists of GHRH represent a promising pharmacological therapy aimed at promoting islet graft growth and proliferation in diabetic patients. |
|
Ranchin B, Boury-Jamot M, Blanchard G, Dubourg L, Hadj-Aïssa A, Morin D, Durroux T, Cochat P, Bricca G, Verbavatz JM, Geelen G
|
Familial nephrogenic syndrome of inappropriate antidiuresis: dissociation between aquaporin-2 and vasopressin excretion.
|
J. Clin. Endocrinol. Metab. 2010 Sep 14;95(9):E37-43
|
|
Cell Biology
|

|
20631022 |
|
Nephrogenic syndrome of inappropriate antidiuresis (NSIAD), the X-linked disease resulting from activating mutation of the vasopressin V2 receptor gene (AVPR2), is a recently described condition causative of episodes of hyponatremia in boys and male and female adults. |
|
Gruschwitz R, Friedrichs J, Valtink M, Franz CM, Müller DJ, Funk RH, Engelmann K
|
Alignment and cell-matrix interactions of human corneal endothelial cells on nanostructured collagen type I matrices.
|
Invest. Ophthalmol. Vis. Sci. 2010 Dec 14;51(12):6303-10
|
|
Medical Biology
|

|
20631237 |
|
To use nanoscopically defined, two-dimensional matrices assembled from aligned collagen type I fibrils as a sheet substratum for in vitro cultivation of human corneal endothelial cells (HCECs). To assess the effect of matrix architecture on HCEC morphology and to characterize integrin-mediated HCEC-matrix interaction. |
|
Herrgen L, Ares S, Morelli LG, Schröter C, Jülicher F, Oates AC
|
Intercellular coupling regulates the period of the segmentation clock.
|
Curr. Biol. 2010 Jul 27;20(14):1244-53
|
|
Developmental Biology
|

|
20637620 |
|
Coupled biological oscillators can tick with the same period. How this collective period is established is a key question in understanding biological clocks. We explore this question in the segmentation clock, a population of coupled cellular oscillators in the vertebrate embryo that sets the rhythm of somitogenesis, the morphological segmentation of the body axis. The oscillating cells of the zebrafish segmentation clock are thought to possess noisy autonomous periods, which are synchronized by intercellular coupling through the Delta-Notch pathway. Here we ask whether Delta-Notch coupling additionally influences the collective period of the segmentation clock. |
|
Schröter C, Oates AC
|
Segment number and axial identity in a segmentation clock period mutant.
|
Curr. Biol. 2010 Jul 27;20(14):1254-8
|
|
Developmental Biology
|

|
20637625 |
|
A species-specific number of segments is a hallmark of the vertebrate body plan. The first segmental structures in the vertebrate embryo are the somites, which bud sequentially from the growing presomitic mesoderm (PSM). The Clock and Wavefront model for somitogenesis proposes that the total number of somites is determined by the period of an oscillator or clock operating in the PSM and the total duration of PSM growth. Furthermore, the number of oscillations of the segmentation clock has been suggested to regulate the regional identity of segments along the body axis. Here we test these two ideas in a zebrafish mutant in which the segmentation clock is specifically slowed. This reduces segment number as predicted, but hox gene expression and posterior anatomical markers align with lower segmental counts in mutants compared to the wild-type, arguing against an instructive role of the segmentation clock in determining axial identities. Our data therefore suggest that precise control of segmentation clock period in relation to axial growth ensures a species-specific segment number and that during evolution modulating the clock's period through genetic mutations may have been a relevant way to vary segment number independently of axial regionalization. |
|
Reynaud EG, Tomancak P
|
Meeting report: first light sheet based fluorescence microscopy workshop.
|
Biotechnol J 2010 Aug;5(8):798-804
|
|
Imaging Technologies Development
|

|
20652906 |
|
|
|
Reichardt K, Jacobs E, Röske I, Helbig JH
|
Legionella pneumophila carrying the virulence-associated lipopolysaccharide epitope possesses two functionally different LPS components.
|
Microbiology (Reading, Engl.) 2010 Oct 23;156(Pt 10):2953-61
|
|
Medical Biology
|

|
20656784 |
|
Phase-variable expression of Legionella pneumophila lipopolysaccharide (LPS) has not been described in detail for strains possessing the virulence-associated epitope recognized by the monoclonal antibody (mAb) 3/1 of the Dresden Panel. About 75?% of cases of community-acquired legionellosis are caused by mAb 3/1-positive strains. In this study, the LPS architecture of the mAb 3/1-positive Corby strain was investigated during its life cycle in broth culture and inside monocytic host cells. During the exponential growth phase in broth, the highly acetylated and therefore strongly hydrophobic mAb 3/1 epitope is expressed continuously, but only 3?% of the bacteria can be detected using mAb 59/1, which recognizes a short-chain variant of the Legionella LPS that is less hydrophobic due to missing acetylations of the O-chain. The percentage of mAb 59/1-positive legionellae increases up to 34?% in the post-exponential growth phase. LPS shed in broth during the exponential phase is mAb 59/1-negative, and mAb 3/1-positive components do not possess short-chain molecules. The LPS pattern expressed and shed inside U937 cells and A/J mouse macrophages points to the same regulatory mechanisms. During the so-called 'pregnant pause', the period for establishment of the replicative phagosomes, the mAb 3/1-positive LPS is shed into the phagosome and seems to pass through the phagosomal membrane, while mAb 59/1-positive LPS is detectable only on the bacterial surface. After egress of the legionellae into the cytoplasm followed by host cell lysis, individual bacteria are mAb 3/1-positive and mAb 59/1-negative. Intracellularly formed Legionella clusters consist of surface-located mAb 3/1-positive bacteria, which are predominantly mAb 59/1-negative. They surround less hydrophobic and therefore closely packed mAb 59/1-positive bacteria. Based on the different degrees of hydrophobicity, bacteria are able to support the expression of two functionally different LPS architectures, namely more hydrophobic LPS for surviving in aerosols and more hydrophilic LPS for close-packing of legionellae inside clusters. |
|
Korkmaz N, Ostermann K, Rödel G
|
Expression and assembly of recombinant surface layer proteins in Saccharomyces cerevisiae.
|
Curr. Microbiol. 2011 Feb 25;62(2):366-73
|
|
Cell Biology
|

|
20658344 |
|
Most bacterial surface layers (SLs) are formed by self-assembly of a single type of protein. Native and recombinant surface layer monomers are capable to self-assemble on solid substrates and in solution to highly regular nanosized arrays which make them attractive for nanobiotechnological applications. In this study, we expressed the surface layer protein SbsC of Bacillus stearothermophilus ATTC 12980, tagged with Enhanced Green Fluorescent Protein, in the yeast Saccharomyces cerevisiae. We observed a network of tubular structures in the cytosol of the transformed yeast cells that did not colocalize with microtubules or the actin cytoskeleton. Time-resolved analysis of the formation of these structures during vegetative growth and sporulation was investigated by live fluorescence microscopy. While in meiosis ascospores seemed to receive assembled structures from the diploid cells, during mitosis, SL structures were formed de novo in the buds. SL assembly always started with the appearance of a dot-like structure in the cytoplasm, suggesting a single nucleation point. |
|
Fonseca AV, Freund D, Bornhäuser M, Corbeil D
|
Polarization and migration of hematopoietic stem and progenitor cells rely on the RhoA/ROCK I pathway and an active reorganization of the microtubule network.
|
J. Biol. Chem. 2010 Oct 8;285(41):31661-71
|
|
Cell Biology
|

|
20682776 |
|
Understanding the physiological migration of hematopoietic progenitors is important, not only for basic stem cell research, but also in view of their therapeutic relevance. Here, we investigated the role of the Rho kinase pathway in the morphology and migration of hematopoietic progenitors using an ex vivo co-culture consisting of human primary CD34(+) progenitors and mesenchymal stromal cells. The addition of the Rho kinase inhibitor Y-27632 led to the abolishment of the uropod and microvillar-like structures of hematopoietic progenitors, concomitant with a redistribution of proteins found therein (prominin-1 and ezrin). Y-27632-treated cells displayed a deficiency in migration. Time-lapse video microscopy revealed impairment of the rear pole retraction. Interestingly, the knockdown of ROCK I, but not ROCK II, using RNA interference (RNAi) was sufficient to cause the referred morphological and migrational changes. Unexpectedly, the addition of nocodazole to either Y-27632- or ROCK I RNAi-treated cells could restore their polarized morphology and migration suggesting an active role for the microtubule network in tail retraction. Finally, we could demonstrate using RNAi that RhoA, the upstream regulator of ROCK, is involved in these processes. Collectively, our data provide new insights regarding the role of RhoA/ROCK I and the microtubules in the migration of stem cells. |
|
Brankatschk M, Eaton S
|
Lipoprotein particles cross the blood-brain barrier in Drosophila.
|
J. Neurosci. 2010 Aug 4;30(31):10441-7
|
|
Cell Biology
|

|
20685986 |
|
The blood-brain barrier (BBB) regulates passage of nutrients and signaling molecules from the circulation into the brain. Whether lipoproteins cross the BBB in vivo has been controversial, and no clear requirement for circulating lipoproteins in brain development has been shown. We address these issues in Drosophila, which has an functionally conserved BBB, and lipoproteins that resemble those of vertebrates. We show that the Drosophila lipoprotein lipophorin exists in two isoforms. Both isoforms cross the BBB, but accumulate on distinct subsets of cells within the brain. In addition to acting as a lipid carrier, lipophorin carries both sterol-linked and GPI-linked proteins into the circulation and transports them across the BBB. Finally, lipophorin promotes neuroblast proliferation by a mechanism that does not depend on delivery of dietary lipids. Transport of lipophorin and its cargo across the BBB represents a novel mechanism by which peripherally synthesized proteins might enter the brain and influence its development. Furthermore, lipid-linkage may be an efficient method to transport therapeutic molecules across the BBB. |
|
Redemann S, Pecreaux J, Goehring NW, Khairy K, Stelzer EH, Hyman AA, Howard J
|
Membrane invaginations reveal cortical sites that pull on mitotic spindles in one-cell C. elegans embryos.
|
PLoS ONE 2010 Aug 20;5(8):e12301
|
|
Cell Biology
|

|
20808841 |
|
Asymmetric positioning of the mitotic spindle in C. elegans embryos is mediated by force-generating complexes that are anchored at the plasma membrane and that pull on microtubules growing out from the spindle poles. Although asymmetric distribution of the force generators is thought to underlie asymmetric positioning of the spindle, the number and location of the force generators has not been well defined. In particular, it has not been possible to visualize individual force generating events at the cortex. We discovered that perturbation of the acto-myosin cortex leads to the formation of long membrane invaginations that are pulled from the plasma membrane toward the spindle poles. Several lines of evidence show that the invaginations, which also occur in unperturbed embryos though at lower frequency, are pulled by the same force generators responsible for spindle positioning. Thus, the invaginations serve as a tool to localize the sites of force generation at the cortex and allow us to estimate a lower limit on the number of cortical force generators within the cell. |
|
Aigouy B, Farhadifar R, Staple DB, Sagner A, Röper JC, Jülicher F, Eaton S
|
Cell flow reorients the axis of planar polarity in the wing epithelium of Drosophila.
|
Cell 2010 Sep 3;142(5):773-86
|
|
Developmental Biology
|

|
20813263 |
|
Planar cell polarity (PCP) proteins form polarized cortical domains that govern polarity of external structures such as hairs and cilia in both vertebrate and invertebrate epithelia. The mechanisms that globally orient planar polarity are not understood, and are investigated here in the Drosophila wing using a combination of experiment and theory. Planar polarity arises during growth and PCP domains are initially oriented toward the well-characterized organizer regions that control growth and patterning. At pupal stages, the wing hinge contracts, subjecting wing-blade epithelial cells to anisotropic tension in the proximal-distal axis. This results in precise patterns of oriented cell elongation, cell rearrangement and cell division that elongate the blade proximo-distally and realign planar polarity with the proximal-distal axis. Mutation of the atypical Cadherin Dachsous perturbs the global polarity pattern by altering epithelial dynamics. This mechanism utilizes the cellular movements that sculpt tissues to align planar polarity with tissue shape. |
|
Pulvers JN, Bryk J, Fish JL, Wilsch-Bräuninger M, Arai Y, Schreier D, Naumann R, Helppi J, Habermann B, Vogt J, Nitsch R, Tóth A, Enard W, Pääbo S, Huttner WB
|
Mutations in mouse Aspm (abnormal spindle-like microcephaly associated) cause not only microcephaly but also major defects in the germline.
|
Proc. Natl. Acad. Sci. U.S.A. 2010 Sep 21;107(38):16595-600
|
|
Developmental Biology
|

|
20823249 |
|
Mutations in ASPM (abnormal spindle-like microcephaly associated) cause primary microcephaly in humans, a disorder characterized by a major reduction in brain size in the apparent absence of nonneurological anomalies. The function of the Aspm protein in neural progenitor cell expansion, as well as its localization to the mitotic spindle and midbody, suggest that it regulates brain development by a cell division-related mechanism. Furthermore, evidence that positive selection affected ASPM during primate evolution has led to suggestions that such a function changed during primate evolution. Here, we report that in Aspm mutant mice, truncated Aspm proteins similar to those causing microcephaly in humans fail to localize to the midbody during M-phase and cause mild microcephaly. A human ASPM transgene rescues this phenotype but, interestingly, does not cause a gain of function. Strikingly, truncated Aspm proteins also cause a massive loss of germ cells, resulting in a severe reduction in testis and ovary size accompanied by reduced fertility. These germline effects, too, are fully rescued by the human ASPM transgene, indicating that ASPM is functionally similar in mice and humans. Our findings broaden the spectrum of phenotypic effects of ASPM mutations and raise the possibility that positive selection of ASPM during primate evolution reflects its function in the germline. |
|
Rentsch C, Rentsch B, Breier A, Spekl K, Jung R, Manthey S, Scharnweber D, Zwipp H, Biewener A
|
Long-bone critical-size defects treated with tissue-engineered polycaprolactone-co-lactide scaffolds: a pilot study on rats.
|
J Biomed Mater Res A 2010 Dec 1;95(3):964-72
|
|
Medical Biology
|

|
20824650 |
|
The aim of this study was to evaluate the osteogenic potential of embroidered, tissue-engineered polycaprolactone-co-lactide (trade name: PCL) scaffolds for the reconstruction of large bone defects. Ten piled-up PCL scaffolds were implanted in femura with a critical size defect of immunodeficient nude rats for 12 weeks [n = 4, group 1: noncoated, group 2: collagen I (coll I), group 3: collagen I/chondroitin sulfate (coll I/CS), and group 4: collagen I/chondroitin sulfate/human mesenchymal stem cells (coll I/CS/hMSC)]. X-ray examination, computer tomography, and histological analyses of the explanted scaffold pads were performed. The quantification of the bone volume ratio showed a significantly higher rate of new bone formation at coll I/CS-coated scaffolds compared with the other groups. Histological investigations revealed that the defect reconstruction started from the peripheral bone ends and incorporated into the scaffold material. Additionally seeded hMSC on coll I/CS-coated scaffolds showed a higher matrix deposition inside the implant but no higher bone formation was observed. These data imply that the coll I/CS-coated PCL scaffolds have the highest potential for treating critical size defects. The scaffolds, being variable in size and structure, can be adapted to any bone defect. |
|
Mayer M, Depken M, Bois JS, Jülicher F, Grill SW
|
Anisotropies in cortical tension reveal the physical basis of polarizing cortical flows.
|
Nature 2010 Sep 30;467(7315):617-21
|
|
Biophysics
|

|
20852613 |
|
Asymmetric cell divisions are essential for the development of multicellular organisms. To proceed, they require an initially symmetric cell to polarize. In Caenorhabditis elegans zygotes, anteroposterior polarization is facilitated by a large-scale flow of the actomyosin cortex, which directs the asymmetry of the first mitotic division. Cortical flows appear in many contexts of development, but their underlying forces and physical principles remain poorly understood. How actomyosin contractility and cortical tension interact to generate large-scale flow is unclear. Here we report on the subcellular distribution of cortical tension in the polarizing C. elegans zygote, which we determined using position- and direction-sensitive laser ablation. We demonstrate that cortical flow is associated with anisotropies in cortical tension and is not driven by gradients in cortical tension, which contradicts previous proposals. These experiments, in conjunction with a theoretical description of active cortical mechanics, identify two prerequisites for large-scale cortical flow: a gradient in actomyosin contractility to drive flow and a sufficiently large viscosity of the cortex to allow flow to be long-ranged. We thus reveal the physical requirements of large-scale intracellular cortical flow that ensure the efficient polarization of the C. elegans zygote. |
|
Klopper AV, Krens G, Grill SW, Heisenberg CP
|
Finite-size corrections to scaling behavior in sorted cell aggregates.
|
Eur Phys J E Soft Matter 2010 Oct 18;33(2):99-103
|
|
Biophysics
|

|
20852912 |
|
Cell sorting is a widespread phenomenon pivotal to the early development of multicellular organisms. In vitro cell sorting studies have been instrumental in revealing the cellular properties driving this process. However, these studies have as yet been limited to two-dimensional analysis of three-dimensional cell sorting events. Here we describe a method to record the sorting of primary zebrafish ectoderm and mesoderm germ layer progenitor cells in three dimensions over time, and quantitatively analyze their sorting behavior using an order parameter related to heterotypic interface length. We investigate the cell population size dependence of sorted aggregates and find that the germ layer progenitor cells engulfed in the final configuration display a relationship between total interfacial length and system size according to a simple geometrical argument, subject to a finite-size effect. |
|
Bulgakova NA, Rentsch M, Knust E
|
Antagonistic functions of two stardust isoforms in Drosophila photoreceptor cells.
|
Mol. Biol. Cell 2010 Nov 15;21(22):3915-25
|
|
Cell Biology
|

|
20861315 |
|
Membrane-associated guanylate kinases (MAGUKs) are scaffolding proteins that organize supramolecular protein complexes, thereby partitioning the plasma membrane into spatially and functionally distinct subdomains. Their modular organization is ideally suited to organize protein complexes with cell type- or stage-specific composition, or both. Often more than one MAGUK isoform is expressed by one gene in the same cell, yet very little is known about their individual in vivo functions. Here, we show that two isoforms of Drosophila stardust, Sdt-H (formerly called Sdt-B2) and Sdt-D, which differ in their N terminus, are expressed in adult photoreceptors. Both isoforms associate with Crumbs and PATJ, constituents of the conserved Crumbs-Stardust complex. However, they form distinct complexes, localized at the stalk, a restricted region of the apical plasma membrane. Strikingly, Sdt-H and Sdt-D have antagonistic functions. While Sdt-H overexpression increases stalk membrane length and prevents light-dependent retinal degeneration, Sdt-D overexpression reduces stalk length and enhances light-dependent retinal degeneration. These results suggest that a fine-tuned balance of different Crumbs complexes regulates photoreceptor homeostasis. |
|
Mishra R, Grzybek M, Niki T, Hirashima M, Simons K
|
Galectin-9 trafficking regulates apical-basal polarity in Madin-Darby canine kidney epithelial cells.
|
Proc. Natl. Acad. Sci. U.S.A. 2010 Oct 12;107(41):17633-8
|
|
Cell Biology
|

|
20861448 |
|
Galectins are unconventionally secreted lectins that participate in the formation of glycoprotein lattices that perform a variety of cell surface functions. Galectins also bind glycosphingolipid headgroups with as yet unclear implications for cellular physiology. We report a specific interaction between galectin-9 and the Forssman glycosphingolipid (FGL) that is important for polarizing Madin-Darby canine kidney epithelial cells. Galectin-9 knockdown leads to a severe loss of epithelial polarity that can be rescued by addition of the recombinant protein. The FGL glycan is identified as the surface receptor that cycles galectin-9 to the Golgi apparatus from which the protein is recycled back to the apical surface. Together our results suggest a model wherein such glycosphingolipid-galectin couples form a circuit between the Golgi apparatus and the cell surface that in an epithelial context facilitates the apical sorting of proteins and lipids. |
|
Müller-Reichert T, Mancuso J, Lich B, McDonald K
|
Three-dimensional reconstruction methods for Caenorhabditis elegans ultrastructure.
|
Methods Cell Biol. 2010;96:331-61
|
- EMF MPI-CBG
- LMF & EMF CFCI
|
Image Processing
|

|
20869530 |
|
The roundworm Caenorhabditis elegans is one of the major model organisms in modern cell and developmental biology. Here, we present methods for the three-dimensional (3D) reconstruction of the worm ultrastructure. We describe the use of (1) serial-section analysis, (2) electron tomography, and (3) serial block face imaging by scanning electron microscopy (SEM). Sample preparation for high-pressure freezing/freeze substitution (HPF/FS) has been extensively covered in a previous volume of this "Methods in Cell Biology" series and will only be described briefly. We will discuss these 3D methods in light of recent research activities related to worm and early embryo biology. |
|
Kurth T, Berger J, Wilsch-Bräuninger M, Kretschmar S, Cerny R, Schwarz H, Löfberg J, Piendl T, Epperlein HH
|
Electron microscopy of the amphibian model systems Xenopus laevis and Ambystoma mexicanum.
|
Methods Cell Biol. 2010;96:395-423
|
- EMF & Histo CMCB
- EMF MPI-CBG
|
Imaging Technologies Development
|

|
20869532 |
|
In this chapter we provide a set of different protocols for the ultrastructural analysis of amphibian (Xenopus, axolotl) tissues, mostly of embryonic origin. For Xenopus these methods include: (1) embedding gastrulae and tailbud embryos into Spurr's resin for TEM, (2) post-embedding labeling of methacrylate (K4M) and cryosections through adult and embryonic epithelia for correlative LM and TEM, and (3) pre-embedding labeling of embryonic tissues with silver-enhanced nanogold. For the axolotl (Ambystoma mexicanum) we present the following methods: (1) SEM of migrating neural crest (NC) cells; (2) SEM and TEM of extracellular matrix (ECM) material; (3) Cryo-SEM of extracellular matrix (ECM) material after cryoimmobilization; and (4) TEM analysis of hyaluronan using high-pressure freezing and HABP labeling. These methods provide exemplary approaches for a variety of questions in the field of amphibian development and regeneration, and focus on cell biological issues that can only be answered with fine structural imaging methods, such as electron microscopy. |
|
Guizetti J, Mäntler J, Müller-Reichert T, Gerlich DW
|
Correlative time-lapse imaging and electron microscopy to study abscission in HeLa cells.
|
Methods Cell Biol. 2010;96:591-601
|
|
Imaging Technologies Development
|

|
20869539 |
|
HeLa cells are widely used as a model system to study cell division. The last step of cell division, abscission, occurs at an about 1 ?m wide intercellular bridge that connects the post-mitotic sister cells. Abscission often occurs long after ingression of the cleavage furrow, and no efficient methods to synchronize cells to this stage are available. Here, we have developed a correlative fluorescence time-lapse imaging and electron microscopic approach using Aclar sheets with engraved grid patterns. This grid pattern, leaving a negative imprint on thin-layer embedded samples, allows identification of cells selected from the time-lapse imaging for serial-section electron microscopy. This method facilitates the ultrastructural analysis of specific stages of abscission. |
|
McDonald K, Schwarz H, Müller-Reichert T, Webb R, Buser C, Morphew M
|
Tips and tricks for high-pressure freezing of model systems.
|
Methods Cell Biol. 2010;96:671-93
|
|
Imaging Technologies Development
|

|
20869543 |
|
High-pressure freezing (HPF) has been around since the mid-1980s as a cryopreparation technique for biological electron microscopy. It has taken quite some time to "catch on" but with the recent interest in cellular tomography and electron microscopy of vitreous cryosections it has been used more frequently. While HPF is relatively easy to do, there are a number of steps, such as loading the sample into the specimen carrier correctly, that are critical to the success of this method. In this chapter we discuss some of the "little" things that can make the difference between successful or unsuccessful freezing. We cover all aspects of HPF, from specimen loading to removing your sample from the carriers in polymerized resin. Our goal is to make it easier and more reliable for HPF users to get well-frozen samples for their research. |
|
Schubert S, Knoch KP, Ouwendijk J, Mohammed S, Bodrov Y, Jäger M, Altkrüger A, Wegbrod C, Adams ME, Kim Y, Froehner SC, Jensen ON, Kalaidzidis Y, Solimena M
|
β2-Syntrophin is a Cdk5 substrate that restrains the motility of insulin secretory granules.
|
PLoS ONE 2010 Sep 23;5(9):e12929
|
|
Medical Biology
|

|
20886068 |
|
The molecular basis for the interaction of insulin granules with the cortical cytoskeleton of pancreatic β-cells remains unknown. We have proposed that binding of the granule protein ICA512 to the PDZ domain of β2-syntrophin anchors granules to actin filaments and that the phosphorylation/dephosphorylation of β2-syntrophin regulates this association. Here we tested this hypothesis by analyzing INS-1 cells expressing GFP-β2-syntrophin through the combined use of biochemical approaches, imaging studies by confocal and total internal reflection fluorescence microscopy as well as electron microscopy. Our results support the notion that β2-syntrophin restrains the mobility of cortical granules in insulinoma INS-1 cells, thereby reducing insulin secretion and increasing insulin stores in resting cells, while increasing insulin release upon stimulation. Using mass spectrometry, in vitro phosphorylation assays and β2-syntrophin phosphomutants we found that phosphorylation of β2-syntrophin on S75 near the PDZ domain decreases its binding to ICA512 and correlates with increased granule motility, while phosphorylation of S90 has opposite effects. We further show that Cdk5, which regulates insulin secretion, phosphorylates S75. These findings provide mechanistic insight into how stimulation displaces insulin granules from cortical actin, thus promoting their motility and exocytosis. |
|
Rumpf C, Cipak L, Schleiffer A, Pidoux A, Mechtler K, Tolić-Nørrelykke IM, Gregan J
|
Laser microsurgery provides evidence for merotelic kinetochore attachments in fission yeast cells lacking Pcs1 or Clr4.
|
Cell Cycle 2010 Oct 1;9(19):3997-4004
|
|
Cell Biology
|

|
20935472 |
|
In order to segregate chromosomes properly, the cell must prevent merotelic kinetochore attachment, an error that occurs when a single kinetochore is attached to microtubules emanating from both spindle poles. Merotelic kinetochore orientation represents a major mechanism of aneuploidy in mitotic mammalian cells and it is the primary mechanism of chromosome instability in cancer cells. Fission yeast mutants defective in putative microtubule-site clamp Pcs1/Mde4 or Clr4/Swi6-dependent centromeric heterochromatin display high frequencies of lagging chromosomes during anaphase. Here, we developed an assay based on laser microsurgery to show that the stretched morphology of lagging kinetochores in pcs1? and clr4? mutant cells is due to merotelic attachment. We further show that Mde4 is regulated by Cdc2 and that Cdc2 activity prevents precocious localization of Mde4 to the metaphase spindle. Finally, we show that Pcs1/Mde4 complex shares similar features with the conserved kinetochore complex Spc24/Spc25 suggesting that these two complexes may occupy a similar functional niche. |
|
Carvalho M, Schwudke D, Sampaio JL, Palm W, Riezman I, Dey G, Gupta GD, Mayor S, Riezman H, Shevchenko A, Kurzchalia TV, Eaton S
|
Survival strategies of a sterol auxotroph.
|
Development 2010 Nov;137(21):3675-85
|
|
Cell Biology
|

|
20940226 |
|
The high sterol concentration in eukaryotic cell membranes is thought to influence membrane properties such as permeability, fluidity and microdomain formation. Drosophila cannot synthesize sterols, but do require them for development. Does this simply reflect a requirement for sterols in steroid hormone biosynthesis, or is bulk membrane sterol also essential in Drosophila? If the latter is true, how do they survive fluctuations in sterol availability and maintain membrane homeostasis? Here, we show that Drosophila require both bulk membrane sterol and steroid hormones in order to complete adult development. When sterol availability is restricted, Drosophila larvae modulate their growth to maintain membrane sterol levels within tight limits. When dietary sterol drops below a minimal threshold, larvae arrest growth and development in a reversible manner. Strikingly, membrane sterol levels in arrested larvae are dramatically reduced (dropping sixfold on average) in most tissues except the nervous system. Thus, sterols are dispensable for maintaining the basic membrane biophysical properties required for cell viability; these functions can be performed by non-sterol lipids when sterols are unavailable. However, bulk membrane sterol is likely to have essential functions in specific tissues during development. In tissues in which sterol levels drop, the overall level of sphingolipids increases and the proportion of different sphingolipid variants is altered. These changes allow survival, but not growth, when membrane sterol levels are low. This relationship between sterols and sphingolipids could be an ancient and conserved principle of membrane homeostasis. |
|
Brandt MD, Maass A, Kempermann G, Storch A
|
Physical exercise increases Notch activity, proliferation and cell cycle exit of type-3 progenitor cells in adult hippocampal neurogenesis.
|
Eur. J. Neurosci. 2010 Oct 08;32(8):1256-64
|
|
Medical Biology
|

|
20950279 |
|
In adult hippocampal neurogenesis of mice, the proliferation of precursor cells can be stimulated by voluntary exercise (wheel-running). Physical activity has an additional effect on late progenitor cells (type-3) by promoting cell survival and further maturation. Notch1 is a key regulator of various steps in neuronal development, including the inhibition of cell cycle exit and neuronal differentiation of neural stem cells, as well as promoting the survival and dendritic branching of newborn neurons. We here report that physical activity increased the proportion and absolute number of doublecortin(+) (DCX) type-2b and type-3 progenitor cells that showed an activated Notch1 pathway. In contrast, the fraction of dividing cells with nuclear Notch intracellular domain expression indicating an activated Notch pathway was not affected by physical exercise. We used double labeling with two halogenated thymidine analogs, iododeoxyuridine and chlorodeoxyuridine, to distinguish between cell cycle exit and continued division at the progenitor cell level. After 7 days of physical exercise, the proliferative activity of precursor cells was increased, whereas the proportion of type-2b/3 cells re-entering S-phase was reduced. Consistent with this observation, the proportion of DCX(+) cells that expressed the marker of postmitotic immature granule cells (calretinin) was enhanced. Running promotes both the proliferation and cell cycle exit of DCX(+) type-3 precursors, possibly by preferentially stimulating a last neurogenic cell division. These pro-proliferative effects are independent of Notch1, whereas the running-induced survival and cell cycle exit of type-3 progenitor cells might by mediated by Notch1 activity. |
|
Cardona A, Saalfeld S, Preibisch S, Schmid B, Cheng A, Pulokas J, Tomančák P, Hartenstein V
|
An integrated micro- and macroarchitectural analysis of the Drosophila brain by computer-assisted serial section electron microscopy.
|
PLoS Biol. 2010 Oct 05;8(10)
|
|
Image Processing
|

|
20957184 |
|
The analysis of microcircuitry (the connectivity at the level of individual neuronal processes and synapses), which is indispensable for our understanding of brain function, is based on serial transmission electron microscopy (TEM) or one of its modern variants. Due to technical limitations, most previous studies that used serial TEM recorded relatively small stacks of individual neurons. As a result, our knowledge of microcircuitry in any nervous system is very limited. We applied the software package TrakEM2 to reconstruct neuronal microcircuitry from TEM sections of a small brain, the early larval brain of Drosophila melanogaster. TrakEM2 enables us to embed the analysis of the TEM image volumes at the microcircuit level into a light microscopically derived neuro-anatomical framework, by registering confocal stacks containing sparsely labeled neural structures with the TEM image volume. We imaged two sets of serial TEM sections of the Drosophila first instar larval brain neuropile and one ventral nerve cord segment, and here report our first results pertaining to Drosophila brain microcircuitry. Terminal neurites fall into a small number of generic classes termed globular, varicose, axiform, and dendritiform. Globular and varicose neurites have large diameter segments that carry almost exclusively presynaptic sites. Dendritiform neurites are thin, highly branched processes that are almost exclusively postsynaptic. Due to the high branching density of dendritiform fibers and the fact that synapses are polyadic, neurites are highly interconnected even within small neuropile volumes. We describe the network motifs most frequently encountered in the Drosophila neuropile. Our study introduces an approach towards a comprehensive anatomical reconstruction of neuronal microcircuitry and delivers microcircuitry comparisons between vertebrate and insect neuropile. |
|
Goehring NW, Chowdhury D, Hyman AA, Grill SW
|
FRAP analysis of membrane-associated proteins: lateral diffusion and membrane-cytoplasmic exchange.
|
Biophys. J. 2010 Oct 20;99(8):2443-52
|
|
Biophysics
|

|
20959084 |
|
Obtaining quantitative kinetic parameters from fluorescence recovery after photobleaching (FRAP) experiments generally requires a theoretical analysis of protein mobility and appropriate solutions for FRAP recovery derived for a given geometry. Here we provide a treatment of FRAP recovery for a molecule undergoing a combined process of reversible membrane association and lateral diffusion on the plasma membrane for two commonly used bleach geometries: stripes, and boxes. Such analysis is complicated by the fact that diffusion of a molecule during photobleaching can lead to broadening of the bleach area, resulting in significant deviations of the actual bleach shape from the desired bleach geometry, which creates difficulty in accurately measuring kinetic parameters. Here we overcome the problem of deviations between actual and idealized bleach geometries by parameterizing, more accurately, the initial postbleach state. This allows for reconstruction of an accurate and analytically tractable approximation of the actual fluorescence distribution. Through simulated FRAP experiments, we demonstrate that this method can be used to accurately measure a broad range of combinations of diffusion constants and exchange rates. Use of this method to analyze the plextrin homology domain of PLC-?1 in Caenorhabditis elegans results in quantitative agreement with prior analysis of this domain in other cells using other methods. Because of the flexibility, relative ease of implementation, and its use of standard, easily obtainable bleach geometries, this method should be broadly applicable to investigation of protein dynamics at the plasma membrane. |
|
Quesada-Hernández E, Caneparo L, Schneider S, Winkler S, Liebling M, Fraser SE, Heisenberg CP
|
Stereotypical cell division orientation controls neural rod midline formation in zebrafish.
|
Curr. Biol. 2010 Nov 9;20(21):1966-72
|
|
Developmental Biology
|

|
20970340 |
|
The development of multicellular organisms is dependent on the tight coordination between tissue growth and morphogenesis. The stereotypical orientation of cell divisions has been proposed to be a fundamental mechanism by which proliferating and growing tissues take shape. However, the actual contribution of stereotypical division orientation (SDO) to tissue morphogenesis is unclear. In zebrafish, cell divisions with stereotypical orientation have been implicated in both body-axis elongation and neural rod formation, although there is little direct evidence for a critical function of SDO in either of these processes. Here we show that SDO is required for formation of the neural rod midline during neurulation but dispensable for elongation of the body axis during gastrulation. Our data indicate that SDO during both gastrulation and neurulation is dependent on the noncanonical Wnt receptor Frizzled 7 (Fz7) and that interfering with cell division orientation leads to severe defects in neural rod midline formation but not body-axis elongation. These findings suggest a novel function for Fz7-controlled cell division orientation in neural rod midline formation during neurulation. |
|
Bechstedt S, Albert JT, Kreil DP, Müller-Reichert T, Göpfert MC, Howard J
|
A doublecortin containing microtubule-associated protein is implicated in mechanotransduction in Drosophila sensory cilia.
|
Nat Commun 2010 Apr 12;1:11
|
|
Cell Biology
|

|
20975667 |
|
Mechanoreceptors are sensory cells that transduce mechanical stimuli into electrical signals and mediate the perception of sound, touch and acceleration. Ciliated mechanoreceptors possess an elaborate microtubule cytoskeleton that facilitates the coupling of external forces to the transduction apparatus. In a screen for genes preferentially expressed in Drosophila campaniform mechanoreceptors, we identified DCX-EMAP, a unique member of the EMAP family (echinoderm-microtubule-associated proteins) that contains two doublecortin domains. DCX-EMAP localizes to the tubular body in campaniform receptors and to the ciliary dilation in chordotonal mechanoreceptors in Johnston's organ, the fly's auditory organ. Adult flies carrying a piggyBac insertion in the DCX-EMAP gene are uncoordinated and deaf and display loss of mechanosensory transduction and amplification. Electron microscopy of mutant sensilla reveals loss of electron-dense materials within the microtubule cytoskeleton in the tubular body and ciliary dilation. Our results establish a catalogue of candidate genes for Drosophila mechanosensation and show that one candidate, DCX-EMAP, is likely to be required for mechanosensory transduction and amplification. |
|
Khairy K, Foo J, Howard J
|
Shapes of Red Blood Cells: Comparison of 3D Confocal Images with the Bilayer-Couple Model.
|
Cell Mol Bioeng 2010 Sep 1;1(2-3):173-181
|
|
Biophysics
|

|
21031149 |
|
Cells and organelles are shaped by the chemical and physical forces that bend cell membranes. The human red blood cell (RBC) is a model system for studying how such forces determine cell morphology. It is thought that RBCs, which are typically biconcave discoids, take the shape that minimizes their membrane-bending energies, subject to the constraints of fixed area and volume. However, recently it has been hypothesized that shear elasticity arising from the membrane-associated cytoskeleton (MS) is necessary to account for shapes of real RBCs, especially ones with highly curved features such as echinocytes. In this work we tested this hypothesis by following RBC shape changes using spherical harmonic series expansions of theoretical cell surfaces and those estimated from 3D confocal microscopy images of live cells. We found (i) quantitative agreement between shapes obtained from the theoretical model including the MS and real cells, (ii) that weakening the MS, by using urea (which denatures spectrin), leads to the theoretically predicted gradual decrease in spicule number of echinocytes, (iii) that the theory predicts that the MS is essential for stabilizing the discocyte morphology against changes in lipid composition, and that without it, the shape would default to the elliptocyte (a biconcave ellipsoid), (iv) that we were able to induce RBCs to adopt the predicted elliptocyte morphology by treating healthy discocytes with urea. The latter observation is consistent with the known connection between the blood disease hereditary elliptocytosis and spectrin mutations that weaken the cell cortex. We conclude that while the discocyte, in absence of shear, is indeed a minimum energy shape, its stabilization in healthy RBCs requires the MS, and that elliptocytosis can be explained based on purely mechanical considerations. |
|
Knopf F, Schnabel K, Haase C, Pfeifer K, Anastassiadis K, Weidinger G
|
Dually inducible TetON systems for tissue-specific conditional gene expression in zebrafish.
|
Proc. Natl. Acad. Sci. U.S.A. 2010 Nov 16;107(46):19933-8
|
|
Imaging Technologies Development
|

|
21041642 |
|
Systems for spatial and temporal control of gene expression are essential for developmental studies and are of particular importance for research in adult model organisms. We present two modified dually inducible TetON systems for tissue-specific conditional control of gene expression in zebrafish based on (i) a tetracycline inducible transcriptional activator (TetActivator) fused to the ligand binding domain of a mutated glucocorticoid receptor (TetA-GBD) and (ii) a TetActivator fused with a domain of the Ecdysone receptor (TetA-EcR). Both systems showed strong induction of tetracycline-responsive promoters upon administration of the appropriate ligands (doxycycline and dexamethasone for TetA-GBD, and doxycycline and tebufenozide for TetA-EcR), and undetectable leakiness when compared with classical TetActivators. Combinations of transgenic lines expressing TetA-GBD specifically in the heart or the CNS with different Tet-responsive transgenic lines allows conditional and tissue-specific control of gene expression in embryos and adults. Importantly, induction is fully reversible and tunable by the doses of drugs used. The TetA-EcR system avoids the possible side effects of dexamethasone and displays improved sensitivity both in zebrafish and in mammalian cells. These results show that dually inducible TetON systems are convenient tools for reversible and very tightly controlled conditional gene expression in zebrafish. |
|
Penkov S, Mende F, Zagoriy V, Erkut C, Martin R, Pässler U, Schuhmann K, Schwudke D, Gruner M, Mäntler J, Reichert-Müller T, Shevchenko A, Knölker HJ, Kurzchalia TV
|
Maradolipids: diacyltrehalose glycolipids specific to dauer larva in Caenorhabditis elegans.
|
Angew. Chem. Int. Ed. Engl. 2010 Dec 3;49(49):9430-5
|
- EMF MPI-CBG
- LMF & EMF CFCI
|
Cell Biology
|

|
21053225 |
|
|
|
Liu Y, Suckale J, Masjkur J, Magro MG, Steffen A, Anastassiadis K, Solimena M
|
Tamoxifen-independent recombination in the RIP-CreER mouse.
|
PLoS ONE 2010 Oct 22;5(10):e13533
|
|
Medical Biology
|

|
21063464 |
|
The inducible Cre-lox system is a valuable tool to study gene function in a spatial and time restricted fashion in mouse models. This strategy relies on the limited background activity of the modified Cre recombinase (CreER) in the absence of its inducer, the competitive estrogen receptor ligand, tamoxifen. The RIP-CreER mouse (Tg (Ins2-cre/Esr1) 1Dam) is among the few available ?-cell specific CreER mouse lines and thus it has been often used to manipulate gene expression in the insulin-producing cells of the endocrine pancreas. |
|
Liang X, Madrid J, Saleh HS, Howard J
|
NOMPC, a member of the TRP channel family, localizes to the tubular body and distal cilium of Drosophila campaniform and chordotonal receptor cells.
|
Cytoskeleton (Hoboken) 2011 Jan;68(1):1-7
|
- EMF & Histo CMCB
- LMF MPI-CBG
|
Cell Biology
|

|
21069788 |
|
Mechanoreception underlies the senses of touch, hearing and balance. An early event in mechanoreception is the opening of ion channels in response to mechanical force impinging on the cell. Here, we report antibody localization of NOMPC, a member of the transient receptor potential (TRP) ion channel family, to the tubular body of campaniform receptors in the halteres and to the distal regions of the cilia of chordotonal neurons in Johnston's organ, the sound-sensing organ of flies. Because NOMPC has been shown to be associated with the mechanotransduction process, our studies suggest that the transduction apparatus in both types of sensory cells is located in regions where a specialized microtubule-based cytoskeleton is in close proximity to an overlying cuticular structure. This localization suggests a transmission route of the mechanical stimulus to the cell. Furthermore, the commonality of NOMPC locations in the two structurally different receptor types suggests a conserved transduction apparatus involving both the intracellular cytoskeleton and the extracellular matrix. |
|
Pan-Montojo FJ, Funk RH
|
Oral administration of rotenone using a gavage and image analysis of alpha-synuclein inclusions in the enteric nervous system.
|
J Vis Exp 2010 Oct 26;(44)
|
|
Neurobiology
|

|
21085094 |
|
In Parkinson's disease (PD) patients, the associated pathology follows a characteristic pattern involving inter alia the enteric nervous system (ENS) (1,2), the olfactory bulb (OB), the dorsal motor nucleus of the vagus (DMV)(3), the intermediolateral nucleus of the spinal cord (4) and the substantia nigra, providing the basis for the neuropathological staging of the disease(4,5). The ENS and the OB are the most exposed nervous structures and the first ones to be affected. Interestingly, PD has been related to pesticide exposure(6-8). Here we show in detail two methods used in our previous study (9). In order to analyze the effects of rotenone acting locally on the ENS, we administered rotenone using a gavage to one-year old C57/BL6 mice. Rotenone is a widely used pesticide that strongly inhibits mitochondrial Complex I (10). It is highly lipophylic and poorly absorbed in the gastrointestinal tract (11). Our results showed that the administration of 5 mg/kg of rotenone did not inhibit mitochondrial Complex I activity in the muscle or the brain. Thus, suggesting that using our administration method rotenone did not cross the hepatoportal system and was acting solely on the ENS. Here we show a method to administer pesticides using a gavage and the image analysis protocol used to analyze the effects of the pesticide in alpha-synuclein accumulation in the ENS. The first part shows a method that allows intragastric administration of pesticides (rotenone) at a desired precise concentration. The second method shows a semi-automatic image analysis protocol to analyze alpha-synuclein accumulation in the ENS using an image analysis software. |
|
Müllers E, Uhlig T, Stirnnagel K, Fiebig U, Zentgraf H, Lindemann D
|
Novel functions of prototype foamy virus Gag glycine- arginine-rich boxes in reverse transcription and particle morphogenesis.
|
J. Virol. 2011 Feb 24;85(4):1452-63
|
|
Medical Biology
|

|
21106749 |
|
Prototype foamy virus (PFV) Gag lacks the characteristic orthoretroviral Cys-His motifs that are essential for various steps of the orthoretroviral replication cycle, such as RNA packaging, reverse transcription, infectivity, integration, and viral assembly. Instead, it contains three glycine-arginine-rich boxes (GR boxes) in its C terminus that putatively represent a functional equivalent. We used a four-plasmid replication-deficient PFV vector system, with uncoupled RNA genome packaging and structural protein translation, to analyze the effects of deletion and various substitution mutations within each GR box on particle release, particle-associated protein composition, RNA packaging, DNA content, infectivity, particle morphology, and intracellular localization. The degree of viral particle release by all mutants was similar to that of the wild type. Only minimal effects on Pol encapsidation, exogenous reverse transcriptase (RT) activity, and genomic viral RNA packaging were observed. In contrast, particle-associated DNA content and infectivity were drastically reduced for all deletion mutants and were undetectable for all alanine substitution mutants. Furthermore, GR box I mutants had significant changes in particle morphology, and GR box II mutants lacked the typical nuclear localization pattern of PFV Gag. Finally, it could be shown that GR boxes I and III, but not GR box II, can functionally complement each other. It therefore appears that, similar to the orthoretroviral Cys-His motifs, the PFV Gag GR boxes are important for RNA encapsidation, genome reverse transcription, and virion infectivity as well as for particle morphogenesis. |
|
Chopin M, Quemeneur L, Ripich T, Jessberger R
|
SWAP-70 controls formation of the splenic marginal zone through regulating T1B-cell differentiation.
|
Eur. J. Immunol. 2010 Dec 11;40(12):3544-56
|
|
Medical Biology
|

|
21108474 |
|
T1 and T2 transitional B cells are precursors for marginal zone B cells (MZB), which surround splenic follicles. MZB are essential for marginal zone formation, are central to the innate immune response, and contribute to adaptive immunity. Differentiation, migration, and homing of MZB and their precursors remain to be fully understood. We show that SWAP-70, a RhoGTPase-interacting and F-actin-binding protein with functions in cell polarization, migration, and adhesion regulates MZB development and marginal zone formation. The percentage of MZB in spleen of Swap70(-/-) mice was reduced to about one-third of that found in WT mice. Swap70(-/-) T1 cells accumulated in integrin ligand(high) regions of the splenic red pulp and failed to efficiently develop into T2 cells. Adoptive transfer and mixed BM chimera experiments demonstrated this to be a B-cell intrinsic phenotype. T-cell-independent antibody production was not impaired, however, and thus suggests that this process does not require correct homing of MZB precursors. B-cell adhesion through ?(L)?(2) and ?(4)?(1) integrins was hyper-activated in vitro and on tissue sections, and S1P-stimulated chemokinesis of MZB was reduced in the absence of SWAP-70. Thus, SWAP-70 acts as a regulator of the adhesion process, particularly important for differentiation control of B-cell precursors and their contribution to splenic tissue formation. |
|
Lange C, Prenninger S, Knuckles P, Taylor V, Levin M, Calegari F
|
The H(+) vacuolar ATPase maintains neural stem cells in the developing mouse cortex.
|
Stem Cells Dev. 2011 May 19;20(5):843-50
|
|
Neurobiology
|

|
21126173 |
|
The vacuolar H(+) ATPase (v-ATPase) is crucial for endosome acidification, endocytosis, and trafficking in essentially all eukaryotic cells. Recent studies have shown that inhibition of the v-ATPase also leads to downregulation of important signaling pathways, including Notch and Wnt, which are key regulators of cell differentiation and tissue homeostasis across the animal kingdom. However, the requirement of endosome acidification and endocytosis in the transduction of Notch signaling is still highly debated. Moreover, no study has yet investigated the role of the v-ATPase during mammalian development. Here we show that expression of a dominant-negative subunit of the v-ATPase in neural precursors of the developing mouse cortex depleted neural stem cells by promoting their differentiation and the generation of neurons. Moreover, inhibition of the v-ATPase reduced endogenous Notch signaling and prevented the proliferative effect of a transmembrane, ?-secretase-dependent, active Notch without blocking the effects of its cytoplasmic intracellular domain (NICD). Our data are consistent with recent reports in Drosophila in which the v-ATPase has been suggested to be important for the transduction of Notch signaling. By extending these reports to mammalian embryos, our data may contribute to a better understanding of the role of the v-ATPase, endosome acidification, and endocytosis in signal transduction during neural stem cell differentiation and brain development. |
|
Spandl J, Lohmann D, Kuerschner L, Moessinger C, Thiele C
|
Ancient ubiquitous protein 1 (AUP1) localizes to lipid droplets and binds the E2 ubiquitin conjugase G2 (Ube2g2) via its G2 binding region.
|
J. Biol. Chem. 2011 Feb 18;286(7):5599-606
|
|
Cell Biology
|

|
21127063 |
|
Lipid droplets (LDs), the major intracellular storage sites for neutral lipids, consist of a neutral lipid core surrounded by a phospholipid monolayer membrane. In addition to their function in lipid storage, LDs participate in lipid biosynthesis and recently were implicated in proteasomal protein degradation and autophagy. To identify components of the protein degradation machinery on LDs, we studied several candidates identified in previous LD proteome analyses. Here, we demonstrate that the highly conserved and broadly expressed ancient ubiquitous protein 1 (AUP1) localizes to LDs, where it integrates into the LD surface in a monotopic fashion with both termini facing the cytosol. AUP1 contains a C-terminal domain with strong homology to a domain known as G2BR, which binds E2 ubiquitin conjugases. We show that AUP1, by means of its G2BR domain, binds to Ube2g2. This binding is abolished by deletion or mutation of the G2BR domain, although the LD localization of AUP1 is not affected. The presence of the AUP1-Ube2g2 complex at LDs provides a direct molecular link between LDs and the cellular ubiquitination machinery. |
|
Levental I, Lingwood D, Grzybek M, Coskun U, Simons K
|
Palmitoylation regulates raft affinity for the majority of integral raft proteins.
|
Proc. Natl. Acad. Sci. U.S.A. 2010 Dec 21;107(51):22050-4
|
|
Cell Biology
|

|
21131568 |
|
The physical basis for protein partitioning into lipid rafts remains an outstanding question in membrane biology that has previously been addressed only through indirect techniques involving differential solubilization by nonionic detergents. We have used giant plasma membrane vesicles, a plasma membrane model system that phase separates to include an ordered phase enriching for raft constituents, to measure the partitioning of the transmembrane linker for activation of T cells (LAT). LAT enrichment in the raft phase was dependent on palmitoylation at two juxtamembrane cysteines and could be enhanced by oligomerization. This palmitoylation requirement was also shown to regulate raft phase association for the majority of integral raft proteins. Because cysteine palmitoylation is the only lipid modification that has been shown to be reversibly regulated, our data suggest a role for palmitoylation as a dynamic raft targeting mechanism for transmembrane proteins. |
|
Riedel F, Vorkel D, Eaton S
|
Megalin-dependent yellow endocytosis restricts melanization in the Drosophila cuticle.
|
Development 2011 Jan;138(1):149-58
|
|
Developmental Biology
|

|
21138977 |
|
The cuticular exoskeleton of arthropods is a composite material comprising well-separated layers that differ in function and molecular constituents. Epidermal cells secrete these layers sequentially, synthesizing components of distal cuticle layers before proximal ones. Could the order of synthesis and secretion be sufficient to account for the precision with which cuticle components localize to specific layers? We addressed this question by studying the spatial restriction of melanization in the Drosophila wing. Melanin formation is confined to a narrow layer within the distal procuticle. Surprisingly, this tight localization depends on the multi-ligand endocytic receptor Megalin (Mgl). Mgl acts, in part, by promoting endocytic clearance of Yellow. Yellow is required for black melanin formation, and its synthesis begins as cuticle is secreted. Near the end of cuticle secretion, its levels drop precipitously by a mechanism that depends on Mgl and Rab5-dependent endocytosis. In the absence of Mgl, Yellow protein persists at higher levels and melanin granules form ectopically in more proximal layers of the procuticle. We propose that the tight localization of the melanin synthesis machinery to the distal procuticle depends not only on the timing of its synthesis and secretion, but also on the rapid clearance of these components before synthesis of subsequent cuticle layers. |
|
Kalinka AT, Varga KM, Gerrard DT, Preibisch S, Corcoran DL, Jarrells J, Ohler U, Bergman CM, Tomancak P
|
Gene expression divergence recapitulates the developmental hourglass model.
|
Nature 2010 Dec 9;468(7325):811-4
|
|
Developmental Biology
|

|
21150996 |
|
The observation that animal morphology tends to be conserved during the embryonic phylotypic period (a period of maximal similarity between the species within each animal phylum) led to the proposition that embryogenesis diverges more extensively early and late than in the middle, known as the hourglass model. This pattern of conservation is thought to reflect a major constraint on the evolution of animal body plans. Despite a wealth of morphological data confirming that there is often remarkable divergence in the early and late embryos of species from the same phylum, it is not yet known to what extent gene expression evolution, which has a central role in the elaboration of different animal forms, underpins the morphological hourglass pattern. Here we address this question using species-specific microarrays designed from six sequenced Drosophila species separated by up to 40 million years. We quantify divergence at different times during embryogenesis, and show that expression is maximally conserved during the arthropod phylotypic period. By fitting different evolutionary models to each gene, we show that at each time point more than 80% of genes fit best to models incorporating stabilizing selection, and that for genes whose evolutionarily optimal expression level is the same across all species, selective constraint is maximized during the phylotypic period. The genes that conform most to the hourglass pattern are involved in key developmental processes. These results indicate that natural selection acts to conserve patterns of gene expression during mid-embryogenesis, and provide a genome-wide insight into the molecular basis of the hourglass pattern of developmental evolution. |
|
Diz-Muñoz A, Krieg M, Bergert M, Ibarlucea-Benitez I, Muller DJ, Paluch E, Heisenberg CP
|
Control of directed cell migration in vivo by membrane-to-cortex attachment.
|
PLoS Biol. 2010 Nov 30;8(11):e1000544
|
|
Cell Biology
|

|
21151339 |
|
Cell shape and motility are primarily controlled by cellular mechanics. The attachment of the plasma membrane to the underlying actomyosin cortex has been proposed to be important for cellular processes involving membrane deformation. However, little is known about the actual function of membrane-to-cortex attachment (MCA) in cell protrusion formation and migration, in particular in the context of the developing embryo. Here, we use a multidisciplinary approach to study MCA in zebrafish mesoderm and endoderm (mesendoderm) germ layer progenitor cells, which migrate using a combination of different protrusion types, namely, lamellipodia, filopodia, and blebs, during zebrafish gastrulation. By interfering with the activity of molecules linking the cortex to the membrane and measuring resulting changes in MCA by atomic force microscopy, we show that reducing MCA in mesendoderm progenitors increases the proportion of cellular blebs and reduces the directionality of cell migration. We propose that MCA is a key parameter controlling the relative proportions of different cell protrusion types in mesendoderm progenitors, and thus is key in controlling directed migration during gastrulation. |
|
Stewart MP, Helenius J, Toyoda Y, Ramanathan SP, Muller DJ, Hyman AA
|
Hydrostatic pressure and the actomyosin cortex drive mitotic cell rounding.
|
Nature 2011 Jan 13;469(7329):226-30
|
|
Biophysics
|

|
21196934 |
|
During mitosis, adherent animal cells undergo a drastic shape change, from essentially flat to round. Mitotic cell rounding is thought to facilitate organization within the mitotic cell and be necessary for the geometric requirements of division. However, the forces that drive this shape change remain poorly understood in the presence of external impediments, such as a tissue environment. Here we use cantilevers to track cell rounding force and volume. We show that cells have an outward rounding force, which increases as cells enter mitosis. We find that this mitotic rounding force depends both on the actomyosin cytoskeleton and the cells' ability to regulate osmolarity. The rounding force itself is generated by an osmotic pressure. However, the actomyosin cortex is required to maintain this rounding force against external impediments. Instantaneous disruption of the actomyosin cortex leads to volume increase, and stimulation of actomyosin contraction leads to volume decrease. These results show that in cells, osmotic pressure is balanced by inwardly directed actomyosin cortex contraction. Thus, by locally modulating actomyosin-cortex-dependent surface tension and globally regulating osmotic pressure, cells can control their volume, shape and mechanical properties. |
|
Krens SF, Möllmert S, Heisenberg CP
|
Enveloping cell-layer differentiation at the surface of zebrafish germ-layer tissue explants.
|
Proc. Natl. Acad. Sci. U.S.A. 2011 Jan 18;108(3):E9-10; author reply E11
|
|
Cell Biology
|

|
21212360 |
|
|
|
Arai Y, Pulvers JN, Haffner C, Schilling B, Nüsslein I, Calegari F, Huttner WB
|
Neural stem and progenitor cells shorten S-phase on commitment to neuron production.
|
Nat Commun 2011 Jan 11;2:154
|
|
Neurobiology
|

|
21224845 |
|
During mammalian cerebral cortex development, the G1-phase of the cell cycle is known to lengthen, but it has been unclear which neural stem and progenitor cells are affected. In this paper, we develop a novel approach to determine cell-cycle parameters in specific classes of neural stem and progenitor cells, identified by molecular markers rather than location. We found that G1 lengthening was associated with the transition from stem cell-like apical progenitors to fate-restricted basal (intermediate) progenitors. Unexpectedly, expanding apical and basal progenitors exhibit a substantially longer S-phase than apical and basal progenitors committed to neuron production. Comparative genome-wide gene expression analysis of expanding versus committed progenitor cells revealed changes in key factors of cell-cycle regulation, DNA replication and repair and chromatin remodelling. Our findings suggest that expanding neural stem and progenitor cells invest more time during S-phase into quality control of replicated DNA than those committed to neuron production. |
|
Sampaio JL, Gerl MJ, Klose C, Ejsing CS, Beug H, Simons K, Shevchenko A
|
Membrane lipidome of an epithelial cell line.
|
Proc. Natl. Acad. Sci. U.S.A. 2011 Feb 1;108(5):1903-7
|
|
Cell Biology
|

|
21245337 |
|
Tissue differentiation is an important process that involves major cellular membrane remodeling. We used Madin-Darby canine kidney cells as a model for epithelium formation and investigated the remodeling of the total cell membrane lipidome during the transition from a nonpolarized morphology to an epithelial morphology and vice versa. To achieve this, we developed a shotgun-based lipidomics workflow that enabled the absolute quantification of mammalian membrane lipidomes with minimal sample processing from low sample amounts. Epithelial morphogenesis was accompanied by a major shift from sphingomyelin to glycosphingolipid, together with an increase in plasmalogen, phosphatidylethanolamine, and cholesterol content, whereas the opposite changes took place during an epithelial-to-mesenchymal transition. Moreover, during polarization, the sphingolipids became longer, more saturated, and more hydroxylated as required to generate an apical membrane domain that serves as a protective barrier for the epithelial sheet. |
|
Nowak M, Machate A, Yu SR, Gupta M, Brand M
|
Interpretation of the FGF8 morphogen gradient is regulated by endocytic trafficking.
|
Nat. Cell Biol. 2011 Feb 23;13(2):153-8
|
|
Cell Biology
|

|
21258372 |
|
Forty years ago, it was proposed that during embryonic development and organogenesis, morphogen gradients provide positional information to the individual cells within a tissue leading to specific fate decisions. Recently, much insight has been gained into how such morphogen gradients are formed and maintained; however, which cellular mechanisms govern their interpretation within target tissues remains debated. Here we used in vivo fluorescence correlation spectroscopy and automated image analysis to assess the role of endocytic sorting dynamics on fibroblast growth factor 8 (Fgf8) morphogen gradient interpretation. By interfering with the function of the ubiquitin ligase Cbl, we found an expanded range of Fgf target gene expression and a delay of Fgf8 lysosomal transport. However, the extracellular Fgf8 morphogen gradient remained unchanged, indicating that the observed signalling changes are due to altered gradient interpretation. We propose that regulation of morphogen signalling activity through endocytic sorting allows fast feedback-induced changes in gradient interpretation during the establishment of complex patterns. |
|
Widlund PO, Stear JH, Pozniakovsky A, Zanic M, Reber S, Brouhard GJ, Hyman AA, Howard J
|
XMAP215 polymerase activity is built by combining multiple tubulin-binding TOG domains and a basic lattice-binding region.
|
Proc. Natl. Acad. Sci. U.S.A. 2011 Feb 15;108(7):2741-6
|
|
Cell Biology
|

|
21282620 |
|
XMAP215/Dis1 family proteins positively regulate microtubule growth. Repeats at their N termini, called TOG domains, are important for this function. While TOG domains directly bind tubulin dimers, it is unclear how this interaction translates to polymerase activity. Understanding the functional roles of TOG domains is further complicated by the fact that the number of these domains present in the proteins of different species varies. Here, we take advantage of a recent crystal structure of the third TOG domain from Caenorhabditis elegans, Zyg9, and mutate key residues in each TOG domain of XMAP215 that are predicted to be important for interaction with the tubulin heterodimer. We determined the contributions of the individual TOG domains to microtubule growth. We show that the TOG domains are absolutely required to bind free tubulin and that the domains differentially contribute to XMAP215's overall affinity for free tubulin. The mutants' overall affinity for free tubulin correlates well with polymerase activity. Furthermore, we demonstrate that an additional basic region is important for targeting to the microtubule lattice and is critical for XMAP215 to function at physiological concentrations. Using this information, we have engineered a "bonsai" protein, with two TOG domains and a basic region, that has almost full polymerase activity. |
|
Guizetti J, Schermelleh L, Mäntler J, Maar S, Poser I, Leonhardt H, Müller-Reichert T, Gerlich DW
|
Cortical constriction during abscission involves helices of ESCRT-III-dependent filaments.
|
Science 2011 Mar 25;331(6024):1616-20
|
- EMF MPI-CBG
- LMF MPI-CBG
- LMF & EMF CFCI
|
Cell Biology
|

|
21310966 |
|
After partitioning of cytoplasmic contents by cleavage furrow ingression, animal cells remain connected by an intercellular bridge, which subsequently splits by abscission. Here, we examined intermediate stages of abscission in human cells by using live imaging, three-dimensional structured illumination microscopy, and electron tomography. We identified helices of 17-nanometer-diameter filaments, which narrowed the cortex of the intercellular bridge to a single stalk. The endosomal sorting complex required for transport (ESCRT)-III co-localized with constriction zones and was required for assembly of 17-nanometer-diameter filaments. Simultaneous spastin-mediated removal of underlying microtubules enabled full constriction at the abscission site. The identification of contractile filament helices at the intercellular bridge has broad implications for the understanding of cell division and of ESCRT-III-mediated fission of large membrane structures. |
|
Pabis M, Neufeld N, Shav-Tal Y, Neugebauer KM
|
Binding properties and dynamic localization of an alternative isoform of the cap-binding complex subunit CBP20.
|
Nucleus 2010 Sep-Oct;1(5):412-21
|
|
Cell Biology
|

|
21326824 |
7-methyl guanosine; CBC; CBP20; alternative splicing; nucleolar caps |
The nuclear cap-binding complex (CBC) is a heterodimer composed of CBP20 and CBP80 subunits and has roles in the biogenesis of messenger RNAs (mRNAs), small nuclear RNAs (snRNAs) and microRNAs. CBP20 is a phylogenetically conserved protein that interacts with the 7-methyl guanosine (m7G) cap added to the 5' end of all RNA polymerase II transcripts. CBP80 ensures high affinity binding of the cap by CBP20 and provides a platform for interactions with other factors. Here we characterize an alternative splice variant of CBP20, termed CBP20S. The CBP20S transcript has an in-frame deletion, leading to the translation of a protein lacking most of the RNA recognition motif (RRM). We show that CBP20S is conserved among mammalian species and is expressed in human cell lines and bone marrow cells. Unlike the full-length CBP20, CBP20S does not bind CBP80 or the m7G cap. Nevertheless, CBP20S does bind mRNA, is localized to an active transcription site and redistributed to nucleolar caps upon transcription inhibition. Our results suggest that this novel form CBP20S plays a role in transcription and/or RNA processing independent of CBP80 or the cap. |
|
Strzelecka M, Oates AC, Neugebauer KM
|
Dynamic control of Cajal body number during zebrafish embryogenesis.
|
Nucleus 2010 Jan-Feb;1(1):96-108
|
|
Developmental Biology
|

|
21327108 |
Cajal body; pre-mRNA splicing; scaRNA; snRNA; snRNP; zygotic gene expression |
The Cajal body (CB) is an evolutionarily conserved nuclear subcompartment, enriched in components of the RNA processing machinery. The composition and dynamics of CBs in cells of living organisms is not well understood. Here we establish the zebrafish embryo as a model system to investigate the properties of CBs during rapid growth and cell division, taking advantage of the ease of live-cell imaging. We show that zebrafish embryo CBs contain coilin and multiple components of the pre-mRNA splicing machinery. Histone mRNA 3' end processing factors, present in CBs in some systems, were instead concentrated in a distinct nuclear body. CBs were present in embryos before and after activation of zygotic gene expression, indicating a maternal contribution of CB components. During the first 24 hours of development, embryonic cells displayed up to 30 CBs per nucleus; these dispersed prior to mitosis and reassembled within minutes upon daughter cell nucleus formation. Following zygotic genome activation, snRNP biogenesis was required for CB assembly and maintenance, suggesting a self-assembly process that determines CB numbers in embryos. Differentiation into muscle, neurons and epidermis was associated with the achievement of a steady state number of 2 CBs per nucleus. We propose that CB number is regulated during development to respond to the demands of gene expression in a rapidly growing embryo. |
|
Brangwynne CP, Mitchison TJ, Hyman AA
|
Active liquid-like behavior of nucleoli determines their size and shape in Xenopus laevis oocytes.
|
Proc. Natl. Acad. Sci. U.S.A. 2011 Mar 15;108(11):4334-9
|
|
Developmental Biology
|

|
21368180 |
|
For most intracellular structures with larger than molecular dimensions, little is known about the connection between underlying molecular activities and higher order organization such as size and shape. Here, we show that both the size and shape of the amphibian oocyte nucleolus ultimately arise because nucleoli behave as liquid-like droplets of RNA and protein, exhibiting characteristic viscous fluid dynamics even on timescales of < 1 min. We use these dynamics to determine an apparent nucleolar viscosity, and we show that this viscosity is ATP-dependent, suggesting a role for active processes in fluidizing internal contents. Nucleolar surface tension and fluidity cause their restructuring into spherical droplets upon imposed mechanical deformations. Nucleoli exhibit a broad distribution of sizes with a characteristic power law, which we show is a consequence of spontaneous coalescence events. These results have implications for the function of nucleoli in ribosome subunit processing and provide a physical link between activity within a macromolecular assembly and its physical properties on larger length scales. |
|
Jakobsen L, Vanselow K, Skogs M, Toyoda Y, Lundberg E, Poser I, Falkenby LG, Bennetzen M, Westendorf J, Nigg EA, Uhlen M, Hyman AA, Andersen JS
|
Novel asymmetrically localizing components of human centrosomes identified by complementary proteomics methods.
|
EMBO J. 2011 Apr 20;30(8):1520-35
|
|
Cell Biology
|

|
21399614 |
|
Centrosomes in animal cells are dynamic organelles with a proteinaceous matrix of pericentriolar material assembled around a pair of centrioles. They organize the microtubule cytoskeleton and the mitotic spindle apparatus. Mature centrioles are essential for biogenesis of primary cilia that mediate key signalling events. Despite recent advances, the molecular basis for the plethora of processes coordinated by centrosomes is not fully understood. We have combined protein identification and localization, using PCP-SILAC mass spectrometry, BAC transgeneOmics, and antibodies to define the constituents of human centrosomes. From a background of non-specific proteins, we distinguished 126 known and 40 candidate centrosomal proteins, of which 22 were confirmed as novel components. An antibody screen covering 4000 genes revealed an additional 113 candidates. We illustrate the power of our methods by identifying a novel set of five proteins preferentially associated with mother or daughter centrioles, comprising genes implicated in cell polarity. Pulsed labelling demonstrates a remarkable variation in the stability of centrosomal protein complexes. These spatiotemporal proteomics data provide leads to the further functional characterization of centrosomal proteins. |
|
Jászai J, Fargeas CA, Graupner S, Tanaka EM, Brand M, Huttner WB, Corbeil D
|
Distinct and conserved prominin-1/CD133-positive retinal cell populations identified across species.
|
PLoS ONE 2011 Mar 02;6(3):e17590
|
|
Cell Biology
|

|
21407811 |
|
Besides being a marker of various somatic stem cells in mammals, prominin-1 (CD133) plays a role in maintaining the photoreceptor integrity since mutations in the PROM1 gene are linked with retinal degeneration. In spite of that, little information is available regarding its distribution in eyes of non-mammalian vertebrates endowed with high regenerative abilities. To address this subject, prominin-1 cognates were isolated from axolotl, zebrafish and chicken, and their retinal compartmentalization was investigated and compared to that of their mammalian orthologue. Interestingly, prominin-1 transcripts--except for the axolotl--were not strictly restricted to the outer nuclear layer (i.e., photoreceptor cells), but they also marked distinct subdivisions of the inner nuclear layer (INL). In zebrafish, where the prominin-1 gene is duplicated (i.e., prominin-1a and prominin-1b), a differential expression was noted for both paralogues within the INL being localized either to its vitreal or scleral subdivision, respectively. Interestingly, expression of prominin-1a within the former domain coincided with Pax-6-positive cells that are known to act as progenitors upon injury-induced retino-neurogenesis. A similar, but minute population of prominin-1-positive cells located at the vitreal side of the INL was also detected in developing and adult mice. In chicken, however, prominin-1-positive cells appeared to be aligned along the scleral side of the INL reminiscent of zebrafish prominin-1b. Taken together our data indicate that in addition to conserved expression of prominin-1 in photoreceptors, significant prominin-1-expressing non-photoreceptor retinal cell populations are present in the vertebrate eye that might represent potential sources of stem/progenitor cells for regenerative therapies. |
|
Ocaña-Morgner C, Reichardt P, Chopin M, Braungart S, Wahren C, Gunzer M, Jessberger R
|
Sphingosine 1-phosphate-induced motility and endocytosis of dendritic cells is regulated by SWAP-70 through RhoA.
|
J. Immunol. 2011 May 1;186(9):5345-55
|
|
Medical Biology
|

|
21421853 |
|
The phospholipid mediator sphingosine 1-phosphate (S1P) enhances motility and endocytosis of mature dendritic cells (DCs). We show that in vitro migration of Swap-70(-/-) bone marrow-derived DCs (BMDCs) in response to S1P and S1P-induced upregulation of endocytosis are significantly reduced. S1P-stimulated movement of Swap-70(-/-) BMDCs, specifically retraction of their trailing edge, in a collagen three-dimensional environment is impaired. These in vitro observations correlate with delayed entry into lymphatic vessels and migration to lymph nodes of skin DCs in Swap-70(-/-) mice. Expression of S1P receptors (S1P(1-3)) by wild-type and Swap-70(-/-) BMDCs is similar, but Swap-70(-/-) BMDCs fail to activate RhoA and to localize Rac1 and RhoA into areas of actin polymerization after S1P stimulus. The Rho-activating G protein G?(i) interacts with SWAP-70, which also supports the localization of G?(13) to membrane rafts in BMDCs. LPS-matured Swap-70(-/-) BMDCs contain significantly more active RhoA than wild-type DCs. Preinhibition of Rho activation restored migration to S1P, S1P-induced upregulation of endocytosis in mature Swap-70(-/-) BMDCs, and localization of G?(13) to membrane rafts. These data demonstrate SWAP-70 as a novel regulator of S1P signaling necessary for DC motility and endocytosis. |
|
Suckale J, Wendling O, Masjkur J, Jäger M, Münster C, Anastassiadis K, Stewart AF, Solimena M
|
PTBP1 is required for embryonic development before gastrulation.
|
PLoS ONE 2011 Feb 17;6(2):e16992
|
- LMF MPI-CBG
- LMF & EMF CFCI
|
Medical Biology
|

|
21423341 |
|
Polypyrimidine-tract binding protein 1 (PTBP1) is an important cellular regulator of messenger RNAs influencing the alternative splicing profile of a cell as well as its mRNA stability, location and translation. In addition, it is diverted by some viruses to facilitate their replication. Here, we used a novel PTBP1 knockout mouse to analyse the tissue expression pattern of PTBP1 as well as the effect of its complete removal during development. We found evidence of strong PTBP1 expression in embryonic stem cells and throughout embryonic development, especially in the developing brain and spinal cord, the olfactory and auditory systems, the heart, the liver, the kidney, the brown fat and cartilage primordia. This widespread distribution points towards a role of PTBP1 during embryonic development. Homozygous offspring, identified by PCR and immunofluorescence, were able to implant but were arrested or retarded in growth. At day 7.5 of embryonic development (E7.5) the null mutants were about 5x smaller than the control littermates and the gap in body size widened with time. At mid-gestation, all homozygous embryos were resorbed/degraded. No homozygous mice were genotyped at E12 and the age of weaning. Embryos lacking PTBP1 did not display differentiation into the 3 germ layers and cavitation of the epiblast, which are hallmarks of gastrulation. In addition, homozygous mutants displayed malformed ectoplacental cones and yolk sacs, both early supportive structure of the embryo proper. We conclude that PTBP1 is not required for the earliest isovolumetric divisions and differentiation steps of the zygote up to the formation of the blastocyst. However, further post-implantation development requires PTBP1 and stalls in homozygous null animals with a phenotype of dramatically reduced size and aberration in embryonic and extra-embryonic structures. |
|
Ma E, Goldar A, Verbavatz JM, Marsolier-Kergoat MC
|
Giant yeast cells with nonrecyclable ribonucleotide reductase.
|
Mol. Genet. Genomics 2011 May 27;285(5):415-25
|
|
Cell Biology
|

|
21442328 |
|
Ribonucleotide reductase (RNR) catalyzes the reduction of ribonucleotides to deoxyribonucleotides and thereby provides the precursors required for DNA synthesis and repair. In an attempt to test cell resistance to a permanent replicational stress, we constructed a mutant Saccharomyces cerevisiae strain containing exclusively nonrecyclable catalytic subunits of RNR that become inactivated following the reduction of one ribonucleoside diphosphate. In this rnr1C883A rnr3? mutant, the synthesis of each deoxyribonucleotide thus requires the production of one Rnr1C883A protein, which means that 26 million Rnr1C883A proteins (half the protein complement of a wild-type cell) have to be produced during each cell cycle. rnr1C883A rnr3? cells grow under constant replicational stress, as evidenced by the constitutive activation of the checkpoint effector Rad53, and their S phase is considerably extended compared to the wild type. rnr1C883A rnr3? mutants also display additional abnormalities such as a median cell volume increased by a factor of 8, and the presence of massive inclusion bodies. However, they exhibit a good plating efficiency and can be propagated indefinitely. rnr1C883A rnr3? cells, which can be used as a protein overexpression system, thus illustrate the robustness of S. cerevisiae to multiple physiological parameters. |
|
Laulier C, Barascu A, Guirouilh-Barbat J, Pennarun G, Le Chalony C, Chevalier F, Palierne G, Bertrand P, Verbavatz JM, Lopez BS
|
Bcl-2 inhibits nuclear homologous recombination by localizing BRCA1 to the endomembranes.
|
Cancer Res. 2011 May 15;71(10):3590-602
|
|
Cell Biology
|

|
21444675 |
|
Genetic stability requires coordination of a network of pathways including DNA repair/recombination and apoptosis. In addition to its canonical anti-apoptotic role, Bcl-2 negatively impacts genome stability. In this study, we identified the breast cancer tumor suppressor BRCA1, which plays an essential role in homologous recombination (HR), as a target for Bcl-2 in the repression of HR. Indeed, ionizing radiation-induced BRCA1 foci assembly was repressed when Bcl-2 was expressed ectopically, in human SV40 fibroblasts, or spontaneously, in lymphoma t(14:18) cells and in HeLa and H460 cancer cell lines. Moreover, we showed that the transmembrane (TM) domain of Bcl-2 was required for both inhibition of BRCA1 foci assembly and the inhibition of HR induced by a double-strand break targeted into an intrachromosomal HR substrate by the meganuclease I-SceI. Fluorescence confocal microscopy, proximity ligation assay, and electron microscopy analyses as well as Western blot analysis of subcellular fractions showed that Bcl-2 and BRCA1 colocalized to mitochondria and endoplasmic reticulum in a process requiring the TM domain of Bcl-2. Targeting BRCA1 to the endomembranes depletes BRCA1 from the nucleus and, thus, accounts for the inhibition of HR. Furthermore, our findings support an apoptosis-stimulatory role for the cytosolic form of BRCA1, suggesting a new tumor suppressor function of BRCA1. Together, our results reveal a new mode of BRCA1 regulation and for HR in the maintenance of genome stability. |
|
Wiedmer S, Stange J, Kurth T, Bleiss W, Entzeroth R, Kurth M
|
New insights into the excystation process and oocyst morphology of rodent Eimeria species.
|
Protist 2011 Oct 16;162(4):668-78
|
|
Cell Biology
|

|
21498113 |
|
In this study, the mechanism of excystation of the rodent parasites Eimeria nieschulzi, from rats, and Eimeria falciformis, from mice, was investigated. In vitro, oocysts of both species are susceptible to the protease pepsin, and sporocysts and sporozoites can be excysted in a similar way. Scanning electron microscopy (SEM) revealed a collapse of the oocysts wall at both polar ends after pepsin treatment. This occurs without any visible damage of the outer wall. Using fluorescence and transmission electron microscopy (TEM) we observed that pepsin enters sporulated oocysts at both polar ends and causes degradation of the inner oocyst wall. Using scanning electron microscopy we could identify two polar caps in both investigated rodent Eimeria species, but only one is harbouring the micropyle. Thus the polar caps are the entry site for the pepsin. Furthermore, we provide evidence that the oocyst cap and micropyle are functionally different structures. This study complements the morphological description of both Eimeria species and is of relevance for other coccidian species. |
|
Moessinger C, Kuerschner L, Spandl J, Shevchenko A, Thiele C
|
Human lysophosphatidylcholine acyltransferases 1 and 2 are located in lipid droplets where they catalyze the formation of phosphatidylcholine.
|
J. Biol. Chem. 2011 Jun 17;286(24):21330-9
|
|
Cell Biology
|

|
21498505 |
|
Phosphatidylcholine (PC) is synthesized by two different pathways, the Lands cycle and the Kennedy pathway. The recently identified key enzymes of the Lands cycle, lysophosphatidylcholine acyltransferase 1 and 2 (LPCAT1 and -2), were reported to localize to the endoplasmic reticulum and to function in lung surfactant production and in inflammation response. Here, we show in various mammalian cell lines that both enzymes additionally localize to lipid droplets (LDs), which consist of a core of neutral lipids surrounded by a monolayer of phospholipid, mainly PC. This dual localization is enabled by the monotopic topology of these enzymes demonstrated in this study. Furthermore, we show that LDs have the ability to locally synthesize PC and that this activity correlates with the LPCAT1 and -2 expression level. This suggests that LPCAT1 and -2 have, in addition to their known function in specialized cells, a ubiquitous role in LD-associated lipid metabolism. |
|
Grandel H, Brand M
|
Zebrafish limb development is triggered by a retinoic acid signal during gastrulation.
|
Dev. Dyn. 2011 May 27;240(5):1116-26
|
|
Developmental Biology
|

|
21509893 |
|
Studies in mouse and zebrafish show that vertebrate forelimb development is initiated by retinoic acid (RA). An RA signal leads to transcription of tbx5 in forelimb precursors which is necessary and sufficient for limb development. However, the timing of the RA signaling event has remained controversial as have source tissue and tissue interactions. We have thus determined the contribution of RA to zebrafish pectoral fin development at different developmental stages. Specifically, an early gastrula stage RA signal triggers the process that leads to determination of tbx5-expressing limb precursors, while a later somitogenesis stage RA signal maintains these precursors. Preceding the lack of tbx5-expressing limb precursors in RA deficient zebrafish embryos, aldh1a2 and cyp26a1 expression domains are distorted along the gastrula margin suggesting that positional values in the ventrolateral mesodermal anlagen are affected. We propose that limb precursor determination requires RA dependent specification of lateral plate territories during gastrulation. |
|
Goehring NW, Hoege C, Grill SW, Hyman AA
|
PAR proteins diffuse freely across the anterior-posterior boundary in polarized C. elegans embryos.
|
J. Cell Biol. 2011 May 2;193(3):583-94
|
|
Cell Biology
|

|
21518794 |
|
Polarization of cells by PAR proteins requires the segregation of antagonistic sets of proteins into two mutually exclusive membrane-associated domains. Understanding how nanometer scale interactions between individual PAR proteins allow spatial organization across cellular length scales requires determining the kinetic properties of PAR proteins and how they are modified in space. We find that PAR-2 and PAR-6, which localize to opposing PAR domains, undergo exchange between well mixed cytoplasmic populations and laterally diffusing membrane-associated states. Domain maintenance does not involve diffusion barriers, lateral sorting, or active transport. Rather, both PAR proteins are free to diffuse between domains, giving rise to a continuous boundary flux because of lateral diffusion of molecules down the concentration gradients that exist across the embryo. Our results suggest that the equalizing effects of lateral diffusion are countered by actin-independent differences in the effective membrane affinities of PAR proteins between the two domains, which likely depend on the ability of each PAR species to locally modulate the membrane affinity of opposing PAR species within its domain. We propose that the stably polarized embryo reflects a dynamic steady state in which molecules undergo continuous diffusion between regions of net association and dissociation. |
|
Roehlecke C, Schumann U, Ader M, Knels L, Funk RH
|
Influence of blue light on photoreceptors in a live retinal explant system.
|
Mol. Vis. 2011 Apr 08;17:876-84
|
- EMF & Histo CMCB
- LMF & EMF CFCI
|
Medical Biology
|

|
21527999 |
|
The present study was performed to investigate the early effects of blue light irradiation of photoreceptors in retinal explant cultures. |
|
Schnabel K, Wu CC, Kurth T, Weidinger G
|
Regeneration of cryoinjury induced necrotic heart lesions in zebrafish is associated with epicardial activation and cardiomyocyte proliferation.
|
PLoS ONE 2011 Apr 12;6(4):e18503
|
- EMF & Histo CMCB
- LMF CMCB
|
Developmental Biology
|

|
21533269 |
|
In mammals, myocardial cell death due to infarction results in scar formation and little regenerative response. In contrast, zebrafish have a high capacity to regenerate the heart after surgical resection of myocardial tissue. However, whether zebrafish can also regenerate lesions caused by cell death has not been tested. Here, we present a simple method for induction of necrotic lesions in the adult zebrafish heart based on cryoinjury. Despite widespread tissue death and loss of cardiomyocytes caused by these lesions, zebrafish display a robust regenerative response, which results in substantial clearing of the necrotic tissue and little scar formation. The cellular mechanisms underlying regeneration appear to be similar to those activated in response to ventricular resection. In particular, the epicardium activates a developmental gene program, proliferates and covers the lesion. Concomitantly, mature uninjured cardiomyocytes become proliferative and invade the lesion. Our injury model will be a useful tool to study the molecular mechanisms of natural heart regeneration in response to necrotic cell death. |
|
Prigent M, Boy-Marcotte E, Chesneau L, Gibson K, Dupré-Crochet S, Tisserand H, Verbavatz JM, Cuif MH
|
The RabGAP proteins Gyp5p and Gyl1p recruit the BAR domain protein Rvs167p for polarized exocytosis.
|
Traffic 2011 Aug 13;12(8):1084-97
|
|
Cell Biology
|

|
21554509 |
|
The Rab GTPase-activating proteins (GAP) Gyp5p and Gyl1p are involved in the control of polarized exocytosis at the small-bud stage in Saccharomyces cerevisiae. Both Gyp5p and Gyl1p interact with the N-Bin1/Amphiphysin/Rvs167 (BAR) domain protein Rvs167p, but the biological function of this interaction is unclear. We show here that Gyp5p and Gyl1p recruit Rvs167p to the small-bud tip, where it plays a role in polarized exocytosis. In gyp5?gyl1? cells, Rvs167p is not correctly localized to the small-bud tip. Both P473L mutation in the SH3 domain of Rvs167p and deletion of the proline-rich regions of Gyp5p and Gyl1p disrupt the interaction of Rvs167p with Gyp5p and Gyl1p and impair the localization of Rvs167p to the tips of small buds. We provide evidence for the accumulation of secretory vesicles in small buds of rvs167? cells and for defective Bgl2p secretion in rvs167? cultures enriched in small-budded cells at 13°C, implicating Rvs167p in polarized exocytosis. Moreover, both the accumulation of secretory vesicles in Rvs167p P473L cells cultured at 13°C and secretion defects in cells producing Gyp5p and Gyl1p without proline-rich regions strongly suggest that the function of Rvs167p in exocytosis depends on its ability to interact with Gyp5p and Gyl1p. |
|
Knopf F, Hammond C, Chekuru A, Kurth T, Hans S, Weber CW, Mahatma G, Fisher S, Brand M, Schulte-Merker S, Weidinger G
|
Bone regenerates via dedifferentiation of osteoblasts in the zebrafish fin.
|
Dev. Cell 2011 May 17;20(5):713-24
|
- EMF & Histo CMCB
- LMF CMCB
|
Developmental Biology
|

|
21571227 |
|
While mammals have a limited capacity to repair bone defects, zebrafish can completely regenerate amputated bony structures of their fins. Fin regeneration is dependent on formation of a blastema, a progenitor cell pool accumulating at the amputation plane. It is unclear which cells the blastema is derived from, whether it forms by dedifferentiation of mature cells, and whether blastema cells are multipotent. We show that mature osteoblasts dedifferentiate and form part of the blastema. Osteoblasts downregulate expression of intermediate and late bone differentiation markers and induce genes expressed by bone progenitors. Dedifferentiated osteoblasts proliferate in a FGF-dependent manner and migrate to form part of the blastema. Genetic fate mapping shows that osteoblasts only give rise to osteoblasts in the regenerate, indicating that dedifferentiation is not associated with the attainment of multipotency. Thus, bone can regenerate from mature osteoblasts via dedifferentiation, a finding with potential implications for human bone repair. |
|
Bauer N, Wilsch-Bräuninger M, Karbanová J, Fonseca AV, Strauss D, Freund D, Thiele C, Huttner WB, Bornhäuser M, Corbeil D
|
Haematopoietic stem cell differentiation promotes the release of prominin-1/CD133-containing membrane vesicles--a role of the endocytic-exocytic pathway.
|
EMBO Mol Med 2011 Jul 18;3(7):398-409
|
|
Cell Biology
|

|
21591261 |
|
The differentiation of stem cells is a fundamental process in cell biology and understanding its mechanism might open a new avenue for therapeutic strategies. Using an ex vivo co-culture system consisting of human primary haematopoietic stem and progenitor cells growing on multipotent mesenchymal stromal cells as a feeder cell layer, we describe here the exosome-mediated release of small membrane vesicles containing the stem and cancer stem cell marker prominin-1 (CD133) during haematopoietic cell differentiation. Surprisingly, this contrasts with the budding mechanism underlying the release of this cholesterol-binding protein from plasma membrane protrusions of neural progenitors. Nevertheless, in both progenitor cell types, protein-lipid assemblies might be the essential structural determinant in the release process of prominin-1. Collectively, these data support the concept that prominin-1-containing lipid rafts may host key determinants necessary to maintain stem cell properties and their quantitative reduction or loss may result in cellular differentiation. |
|
Niehage C, Steenblock C, Pursche T, Bornhäuser M, Corbeil D, Hoflack B
|
The cell surface proteome of human mesenchymal stromal cells.
|
PLoS ONE 2011 May 26;6(5):e20399
|
|
Cell Biology
|

|
21637820 |
|
Multipotent human mesenchymal stromal cells (hMSCs) are considered as promising biological tools for regenerative medicine. Their antibody-based isolation relies on the identification of reliable cell surface markers. |
|
Krastev DB, Slabicki M, Paszkowski-Rogacz M, Hubner NC, Junqueira M, Shevchenko A, Mann M, Neugebauer KM, Buchholz F
|
A systematic RNAi synthetic interaction screen reveals a link between p53 and snoRNP assembly.
|
Nat. Cell Biol. 2011 Jul 05;13(7):809-18
|
|
Cell Biology
|

|
21642980 |
|
TP53 (tumour protein 53) is one of the most frequently mutated genes in human cancer and its role during cellular transformation has been studied extensively. However, the homeostatic functions of p53 are less well understood. Here, we explore the molecular dependency network of TP53 through an RNAi-mediated synthetic interaction screen employing two HCT116 isogenic cell lines and a genome-scale endoribonuclease-prepared short interfering RNA library. We identify a variety of TP53 synthetic interactions unmasking the complex connections of p53 to cellular physiology and growth control. Molecular dissection of the TP53 synthetic interaction with UNRIP indicates an enhanced dependency of TP53-negative cells on small nucleolar ribonucleoprotein (snoRNP) assembly. This dependency is mediated by the snoRNP chaperone gene NOLC1 (also known as NOPP140), which we identify as a physiological p53 target gene. This unanticipated function of TP53 in snoRNP assembly highlights the potential of RNAi-mediated synthetic interaction screens to dissect molecular pathways of tumour suppressor genes. |
|
Uddin MS, Lee HK, Preibisch S, Tomancak P
|
Restoration of uneven illumination in light sheet microscopy images.
|
Microsc. Microanal. 2011 Aug 20;17(4):607-13
|
|
Image Processing
|
|
21682937 |
|
Light microscopy images suffer from poor contrast due to light absorption and scattering by the media. The resulting decay in contrast varies exponentially across the image along the incident light path. Classical space invariant deconvolution approaches, while very effective in deblurring, are not designed for the restoration of uneven illumination in microscopy images. In this article, we present a modified radiative transfer theory approach to solve the contrast degradation problem of light sheet microscopy (LSM) images. We confirmed the effectiveness of our approach through simulation as well as real LSM images. |
|
Pocha SM, Wassmer T, Niehage C, Hoflack B, Knust E
|
Retromer controls epithelial cell polarity by trafficking the apical determinant Crumbs.
|
Curr. Biol. 2011 Jul 12;21(13):1111-7
|
|
Cell Biology
|

|
21700461 |
|
The evolutionarily conserved apical determinant Crumbs (Crb) is essential for maintaining apicobasal polarity and integrity of many epithelial tissues [1]. Crb levels are crucial for cell polarity and homeostasis, yet strikingly little is known about its trafficking or the mechanism of its apical localization. Using a newly established, liposome-based system described here, we determined Crb to be an interaction partner and cargo of the retromer complex. Retromer is essential for the retrograde transport of numerous transmembrane proteins from endosomes to the trans-Golgi network (TGN) and is conserved between plants, fungi, and animals [2]. We show that loss of retromer function results in a substantial reduction of Crb in Drosophila larvae, wing discs, and the follicle epithelium. Moreover, loss of retromer phenocopies loss of crb by preventing apical localization of key polarity molecules, such as atypical protein kinase C (aPKC) and Par6 in the follicular epithelium, an effect that can be rescued by overexpression of Crb. Additionally, loss of retromer results in multilayering of the follicular epithelium, indicating that epithelial integrity is severely compromised. Our data reveal a mechanism for Crb trafficking by retromer that is vital for maintaining Crb levels and localization. We also show a novel function for retromer in maintaining epithelial cell polarity. |
|
Levental I, Grzybek M, Simons K
|
Raft domains of variable properties and compositions in plasma membrane vesicles.
|
Proc. Natl. Acad. Sci. U.S.A. 2011 Jul 12;108(28):11411-6
|
|
Cell Biology
|

|
21709267 |
|
Biological membranes are compartmentalized for functional diversity by a variety of specific protein-protein, protein-lipid, and lipid-lipid interactions. A subset of these are the preferential interactions between sterols, sphingolipids, and saturated aliphatic lipid tails responsible for liquid-liquid domain coexistence in eukaryotic membranes, which give rise to dynamic, nanoscopic assemblies whose coalescence is regulated by specific biochemical cues. Microscopic phase separation recently observed in isolated plasma membranes (giant plasma membrane vesicles and plasma membrane spheres) (i) confirms the capacity of compositionally complex membranes to phase separate, (ii) reflects the nanoscopic organization of live cell membranes, and (iii) provides a versatile platform for the investigation of the compositions and properties of the phases. Here, we show that the properties of coexisting phases in giant plasma membrane vesicles are dependent on isolation conditions--namely, the chemicals used to induce membrane blebbing. We observe strong correlations between the relative compositions and orders of the coexisting phases, and their resulting miscibility. Chemically unperturbed plasma membranes reflect these properties and validate the observations in chemically induced vesicles. Most importantly, we observe domains with a continuum of varying stabilities, orders, and compositions induced by relatively small differences in isolation conditions. These results show that, based on the principle of preferential association of raft lipids, domains of various properties can be produced in a membrane environment whose complexity is reflective of biological membranes. |
|
Müllers E, Stirnnagel K, Kaulfuss S, Lindemann D
|
Prototype foamy virus gag nuclear localization: a novel pathway among retroviruses.
|
J. Virol. 2011 Sep 29;85(18):9276-85
|
|
Medical Biology
|

|
21715475 |
|
Gag nuclear localization has long been recognized as a hallmark of foamy virus (FV) infection. Two required motifs, a chromatin-binding site (CBS) and a nuclear localization signal (NLS), both located in glycine-arginine-rich box II (GRII), have been described. However, the underlying mechanisms of Gag nuclear translocation are largely unknown. We analyzed prototype FV (PFV) Gag nuclear localization using a novel live-cell fluorescence microscopy assay. Furthermore, we characterized the nuclear localization route of Gag mutants tagged with the simian vacuolating virus 40-NLS (SV40-NLS) and also dissected the respective contributions of the CBS and the NLS. We found that PFV Gag does not translocate to the nucleus of interphase cells by NLS-mediated nuclear import and does not possess a functional NLS. PFV Gag nuclear localization occurred only by tethering to chromatin during mitosis. This mechanism was found for endogenously expressed Gag as well as for Gag delivered by infecting viral particles. Thereby, the CBS was absolutely essential, while the NLS was dispensable. Gag CBS-dependent nuclear localization was neither essential for infectivity nor necessary for Pol encapsidation. Interestingly, Gag localization was independent of the presence of Pol, Env, and viral RNA. The addition of a heterologous SV40-NLS resulted in the nuclear import of PFV Gag in interphase cells, rescued the nuclear localization deficiency but not the infectivity defect of a PFV Gag ?GRII mutant, and did not enhance FV's ability to infect G(1)/S-phase-arrested cells. Thus, PFV Gag nuclear localization follows a novel pathway among orthoretroviral Gag proteins. |
|
Pranke IM, Morello V, Bigay J, Gibson K, Verbavatz JM, Antonny B, Jackson CL
|
α-Synuclein and ALPS motifs are membrane curvature sensors whose contrasting chemistry mediates selective vesicle binding.
|
J. Cell Biol. 2011 Jul 11;194(1):89-103
|
|
Cell Biology
|

|
21746853 |
|
Membrane curvature sensors have diverse structures and chemistries, suggesting that they might have the intrinsic capacity to discriminate between different types of vesicles in cells. In this paper, we compare the in vitro and in vivo membrane-binding properties of two curvature sensors that form very different amphipathic helices: the amphipathic lipid-packing sensor (ALPS) motif of a Golgi vesicle tether and the synaptic vesicle protein α-synuclein, a causative agent of Parkinson's disease. We demonstrate the mechanism by which α-synuclein senses membrane curvature. Unlike ALPS motifs, α-synuclein has a poorly developed hydrophobic face, and this feature explains its dual sensitivity to negatively charged lipids and to membrane curvature. When expressed in yeast cells, these two curvature sensors were targeted to different classes of vesicles, those of the early secretory pathway for ALPS motifs and to negatively charged endocytic/post-Golgi vesicles in the case of α-synuclein. Through structures with complementary chemistries, α-synuclein and ALPS motifs target distinct vesicles in cells by direct interaction with different lipid environments. |
|
Kurth T, Wiedmer S, Entzeroth R
|
Improvement of ultrastructural preservation of Eimeria oocysts by microwave-assisted chemical fixation or by high pressure freezing and freeze substitution.
|
Protist 2012 Mar 20;163(2):296-305
|
|
Imaging Technologies Development
|

|
21764370 |
|
Fixation and preparation for electron microscopy of coccidian oocysts is a general problem. Especially in sporulated oocysts, proper fixation and resin infiltration are hindered by the robust oocyst wall. Conventional chemical fixation therefore leads to artefacts that obscure cellular details in the oocysts. In this study, sporulated oocysts of Eimeria nieschulzi were subjected to different fixation and embedding protocols: conventional chemical fixation and embedding in Spurr's resin, microwave-assisted fixation and processing followed by embedding in epon, and high pressure freezing followed by freeze substitution and epon embedding. The samples were finally studied by transmission electron microscopy. Many ultrastructural features of the oocyst wall and the sporozoites were already substantially improved after microwaved-assisted fixation and processing. However, the fine structural preservation still suffered from shrinkage and artificial extraction, which occured during dehydration and infiltration. High pressure freezing (HPF) and freeze substitution (FS) revealed much better preservation. Oocyst walls retained their ovoid shape, and the ultrastructure of sporozoites was well preserved with no signs of shrinkage or extraction. HPF and FS are therefore a suitable method for the ultrastructural analysis of coccidian oocysts. |
|
Erkut C, Penkov S, Khesbak H, Vorkel D, Verbavatz JM, Fahmy K, Kurzchalia TV
|
Trehalose renders the dauer larva of Caenorhabditis elegans resistant to extreme desiccation.
|
Curr. Biol. 2011 Aug 9;21(15):1331-6
|
- EMF MPI-CBG
- IPF MPI-CBG
- LMF MPI-CBG
|
Developmental Biology
|

|
21782434 |
|
Water is essential for life on Earth. In its absence, however, some organisms can interrupt their life cycle and temporarily enter an ametabolic state, known as anhydrobiosis [1]. It is assumed that sugars (in particular trehalose) are instrumental for survival under anhydrobiotic conditions [2]. However, the role of trehalose remained obscure because the corresponding evidence was purely correlative and based mostly on in vitro studies without any genetic manipulations of trehalose metabolism. In this study, we used C. elegans as a genetic model to investigate molecular mechanisms of anhydrobiosis. We show that the C. elegans dauer larva is a true anhydrobiote: under defined conditions it can survive even after losing 98% of its body water. This ability is correlated with a several fold increase in the amount of trehalose. Mutants unable to synthesize trehalose cannot survive even mild dehydration. Light and electron microscopy indicate that one of the major functions of trehalose is the preservation of membrane organization. Fourier-transform infrared spectroscopy of whole worms suggests that this is achieved by preserving homogeneous and compact packing of lipid acyl chains. By means of infrared spectroscopy, we can now distinguish a "dry, yet alive" larva from a "dry and dead" one. |
|
Hendruschk S, Wiedemuth R, Aigner A, Töpfer K, Cartellieri M, Martin D, Kirsch M, Ikonomidou C, Schackert G, Temme A
|
RNA interference targeting survivin exerts antitumoral effects in vitro and in established glioma xenografts in vivo.
|
Neuro-oncology 2011 Oct 25;13(10):1074-89
|
|
Medical Biology
|

|
21788344 |
|
Malignant glioma represents the most common primary adult brain tumor in Western industrialized countries. Despite aggressive treatment modalities, the median survival duration for patients with glioblastoma multiforme (GBM), the highest grade malignant glioma, has not improved significantly over past decades. One promising approach to deal with GBM is the inactivation of proteins essential for survival or progression of glioma cells by means of RNA interference (RNAi) techniques. A likely candidate for an RNAi therapy of gliomas is the inhibitor of apoptosis protein survivin. Survivin is involved in 2 main cellular processes-cell division and inhibition of apoptosis. We show here that stable RNAi of survivin induced polyploidy, apoptosis, and impaired proliferation of human U343-MG, U373-MG, H4, and U87-MG cells and of primary glioblastoma cells. Proteome profiler arrays using U373-MG cells identified a novel set of differentially expressed genes upon RNAi-mediated survivin knockdown. In particular, the death receptor TRAIL R2/DR5 was strongly upregulated in survivin-depleted glioma cells, inducing an enhanced cytotoxic response of allogeneic human NK cells. Moreover, an experimental in vivo therapy using polyethylenimine (PEI)/siRNA complexes for survivin knockdown efficiently blocked tumor growth of established subcutaneous U373-MG tumors and enhanced survival of NMRI(nu/nu) mice orthopically transplanted with U87-MG cells. We conclude that survivin is functionally relevant in gliomas and that PEI-mediated exogenous delivery of siRNA targeting survivin is a promising strategy for glioblastoma therapy. |
|
Decker M, Jaensch S, Pozniakovsky A, Zinke A, O'Connell KF, Zachariae W, Myers E, Hyman AA
|
Limiting amounts of centrosome material set centrosome size in C. elegans embryos.
|
Curr. Biol. 2011 Aug 9;21(15):1259-67
|
|
Cell Biology
|

|
21802300 |
|
The ways in which cells set the size of intracellular structures is an important but largely unsolved problem [1]. Early embryonic divisions pose special problems in this regard. Many checkpoints common in somatic cells are missing from these divisions, which are characterized by rapid reductions in cell size and short cell cycles [2]. Embryonic cells must therefore possess simple and robust mechanisms that allow the size of many of their intracellular structures to rapidly scale with cell size. |
|
Michel M, Raabe I, Kupinski AP, Pérez-Palencia R, Bökel C
|
Local BMP receptor activation at adherens junctions in the Drosophila germline stem cell niche.
|
Nat Commun 2011 Aug 02;2:415
|
|
Cell Biology
|

|
21811244 |
|
According to the stem cell niche synapse hypothesis postulated for the mammalian haematopoietic system, spatial specificity of niche signals is maximized by subcellularly restricting signalling to cadherin-based adherens junctions between individual niche and stem cells. However, such a synapse has never been observed directly, in part, because tools to detect active growth factor receptors with subcellular resolution were not available. Here we describe a novel fluorescence-based reporter that directly visualizes bone morphogenetic protein (BMP) receptor activation and show that in the Drosophila testis a BMP niche signal is transmitted preferentially at adherens junctions between hub and germline stem cells, resembling the proposed synapse organization. Ligand secretion involves the exocyst complex and the Rap activator Gef26, both of which are also required for Cadherin trafficking towards adherens junctions. We, therefore, propose that local generation of the BMP signal is achieved through shared use of the Cadherin transport machinery. |
|
Sedzinski J, Biro M, Oswald A, Tinevez JY, Salbreux G, Paluch E
|
Polar actomyosin contractility destabilizes the position of the cytokinetic furrow.
|
Nature 2011 Aug 25;476(7361):462-6
|
|
Cell Biology
|

|
21822289 |
|
Cytokinesis, the physical separation of daughter cells at the end of mitosis, requires precise regulation of the mechanical properties of the cell periphery. Although studies of cytokinetic mechanics mostly focus on the equatorial constriction ring, a contractile actomyosin cortex is also present at the poles of dividing cells. Whether polar forces influence cytokinetic cell shape and furrow positioning remains an open question. Here we demonstrate that the polar cortex makes cytokinesis inherently unstable. We show that limited asymmetric polar contractions occur during cytokinesis, and that perturbing the polar cortex leads to cell shape oscillations, resulting in furrow displacement and aneuploidy. A theoretical model based on a competition between cortex turnover and contraction dynamics accurately accounts for the oscillations. We further propose that membrane blebs, which commonly form at the poles of dividing cells and whose role in cytokinesis has long been enigmatic, stabilize cell shape by acting as valves releasing cortical contractility. Our findings reveal an inherent instability in the shape of the dividing cell and unveil a novel, spindle-independent mechanism ensuring the stability of cleavage furrow positioning. |
|
Schmid J, Ludwig B, Schally AV, Steffen A, Ziegler CG, Block NL, Koutmani Y, Brendel MD, Karalis KP, Simeonovic CJ, Licinio J, Ehrhart-Bornstein M, Bornstein SR
|
Modulation of pancreatic islets-stress axis by hypothalamic releasing hormones and 11beta-hydroxysteroid dehydrogenase.
|
Proc. Natl. Acad. Sci. U.S.A. 2011 Aug 16;108(33):13722-7
|
|
Medical Biology
|

|
21825133 |
|
Corticotropin-releasing hormone (CRH) and growth hormone-releasing hormone (GHRH), primarily characterized as neuroregulators of the hypothalamic-pituitary-adrenal axis, directly influence tissue-specific receptor-systems for CRH and GHRH in the endocrine pancreas. Here, we demonstrate the expression of mRNA for CRH and CRH-receptor type 1 (CRHR1) and of protein for CRHR1 in rat and human pancreatic islets and rat insulinoma cells. Activation of CRHR1 and GHRH-receptor significantly increased cell proliferation and reduced cell apoptosis. CRH stimulated both cellular content and release of insulin in rat islet and insulinoma cells. At the ultrastructural level, CRHR1 stimulation revealed a more active metabolic state with enlarged mitochondria. Moreover, glucocorticoids that promote glucose production are balanced by both 11b-hydroxysteroid dehydrogenase (11?-HSD) isoforms; 11?-HSD-type-1 and 11?-HSD-type-2. We demonstrated expression of mRNA for 11?-HSD-1 and 11?-HSD-2 and protein for 11?-HSD-1 in rat and human pancreatic islets and insulinoma cells. Quantitative real-time PCR revealed that stimulation of CRHR1 and GHRH-receptor affects the metabolism of insulinoma cells by down-regulating 11?-HSD-1 and up-regulating 11?-HSD-2. The 11?-HSD enzyme activity was analyzed by measuring the production of cortisol from cortisone. Similarly, activation of CRHR1 resulted in reduced cortisol levels, indicating either decreased 11?-HSD-1 enzyme activity or increased 11?-HSD-2 enzyme activity; thus, activation of CRHR1 alters the glucocorticoid balance toward the inactive form. These data indicate that functional receptor systems for hypothalamic-releasing hormone agonists exist within the endocrine pancreas and influence synthesis of insulin and the pancreatic glucocorticoid shuttle. Agonists of CRHR1 and GHRH-receptor, therefore, may play an important role as novel therapeutic tools in the treatment of diabetes mellitus. |
|
Galli M, Muñoz J, Portegijs V, Boxem M, Grill SW, Heck AJ, van den Heuvel S
|
aPKC phosphorylates NuMA-related LIN-5 to position the mitotic spindle during asymmetric division.
|
Nat. Cell Biol. 2011 Sep 21;13(9):1132-8
|
|
Cell Biology
|

|
21857670 |
|
The position of the mitotic spindle controls the plane of cell cleavage and determines whether polarized cells divide symmetrically or asymmetrically. In animals, an evolutionarily conserved pathway of LIN-5 (homologues: Mud and NuMA), GPR-1/2 (homologues: Pins, LGN, AGS-3) and G? mediates spindle positioning, and acts downstream of the conserved PAR-3-PAR-6-aPKC polarity complex. However, molecular interactions between polarity proteins and LIN-5-GPR-G? remain to be identified. Here we describe a quantitative mass spectrometry approach for in vivo identification of protein kinase substrates. Applying this strategy to Caenorhabditis elegans embryos, we found that depletion of the polarity kinase PKC-3 results in markedly decreased levels of phosphorylation of a cluster of four LIN-5 serine residues. These residues are directly phosphorylated by PKC-3 in vitro. Phospho-LIN-5 co-localizes with PKC-3 at the anterior cell cortex and temporally coincides with a switch from anterior- to posterior-directed spindle movements in the one-cell embryo. LIN-5 mutations that prevent phosphorylation increase the extent of anterior-directed spindle movements, whereas phosphomimetic mutations decrease spindle migration. Our results indicate that anterior-located PKC-3 inhibits cortical microtubule pulling forces through direct phosphorylation of LIN-5. This molecular interaction between polarity and spindle-positioning proteins may be used broadly in cell cleavage plane determination. |
|
Ganz J, Kaslin J, Freudenreich D, Machate A, Geffarth M, Brand M
|
Subdivisions of the adult zebrafish subpallium by molecular marker analysis.
|
J. Comp. Neurol. 2012 Feb 15;520(3):633-55
|
- EMF & Histo CMCB
- LMF CMCB
|
Neurobiology
|

|
21858823 |
|
The morphology of the telencephalon displays great diversity among different vertebrate lineages. Particularly the everted telencephalon of ray-finned fishes shows a noticeably different morphology from the evaginated telencephalon of nonray-finned fishes and other vertebrates. This makes the comparison between the different parts of the telencephalon of ray-finned fishes and other vertebrates difficult. Based on neuroanatomical, neurochemical, and connectional data no consensus on the subdivisions of the adult telencephalon of ray-finned fishes and their relation to nuclei in the telencephalon of other vertebrates has been reached yet. For tetrapods, comparative expression pattern analysis of homologous developmental genes has been a successful approach to clarify homologies between different parts of the telencephalon. In the larval zebrafish, subdivisions of the subpallium have been proposed using conserved developmental gene expression. In this study, we investigate the subdivisions of the adult zebrafish telencephalon by analyzing the expression pattern of conserved molecular marker genes. We identify the boundary between the pallium and subpallium based on the complementary expression of dlx2a, dlx5a in the subpallium and tbr1, neurod in the pallium. Furthermore, combinatorial expression of Isl, nkx2.1b, lhx1b, tbr1, eomesa, emx1, emx2, and emx3 identifies striatal-like, pallidal-like, and septal-like subdivisions within the subpallium. In contrast to previous models, we propose that the striatum and pallidum are stretched along the rostrocaudal axis of the telencephalon. Further, the septal nuclei derive from both the pallium and subpallium. On this basis, we present a new model for the subdivisions of the subpallium in teleost fish. |
|
García-Sáez AJ, Buschhorn SB, Keller H, Anderluh G, Simons K, Schwille P
|
Oligomerization and pore formation by equinatoxin II inhibit endocytosis and lead to plasma membrane reorganization.
|
J. Biol. Chem. 2011 Oct 28;286(43):37768-77
|
|
Cell Biology
|

|
21885440 |
|
Pore-forming toxins have evolved to induce membrane injury by formation of pores in the target cell that alter ion homeostasis and lead to cell death. Many pore-forming toxins use cholesterol, sphingolipids, or other raft components as receptors. However, the role of plasma membrane organization for toxin action is not well understood. In this study, we have investigated cellular dynamics during the attack of equinatoxin II, a pore-forming toxin from the sea anemone Actinia equina, by combining time lapse three-dimensional live cell imaging, fluorescence recovery after photobleaching, FRET, and fluorescence cross-correlation spectroscopy. Our results show that membrane binding by equinatoxin II is accompanied by extensive plasma membrane reorganization into microscopic domains that resemble coalesced lipid rafts. Pore formation by the toxin induces Ca(2+) entry into the cytosol, which is accompanied by hydrolysis of phosphatidylinositol 4,5-bisphosphate, plasma membrane blebbing, actin cytoskeleton reorganization, and inhibition of endocytosis. We propose that plasma membrane reorganization into stabilized raft domains is part of the killing strategy of equinatoxin II. |
|
Kaiser HJ, Orłowski A, Róg T, Nyholm TK, Chai W, Feizi T, Lingwood D, Vattulainen I, Simons K
|
Lateral sorting in model membranes by cholesterol-mediated hydrophobic matching.
|
Proc. Natl. Acad. Sci. U.S.A. 2011 Oct 4;108(40):16628-33
|
|
Cell Biology
|

|
21930944 |
|
Theoretical studies predict hydrophobic matching between transmembrane domains of proteins and bilayer lipids to be a physical mechanism by which membranes laterally self-organize. We now experimentally study the direct consequences of mismatching of transmembrane peptides of different length with bilayers of different thicknesses at the molecular level. In both model membranes and simulations we show that cholesterol critically constrains structural adaptations at the peptide-lipid interface under mismatch. These constraints translate into a sorting potential and lead to selective lateral segregation of peptides and lipids according to their hydrophobic length. |
|
Kronstein R, Seebach J, Grossklaus S, Minten C, Engelhardt B, Drab M, Liebner S, Arsenijevic Y, Taha AA, Afanasieva T, Schnittler HJ
|
Caveolin-1 opens endothelial cell junctions by targeting catenins.
|
Cardiovasc. Res. 2012 Jan 1;93(1):130-40
|
|
Medical Biology
|

|
21960684 |
|
A fundamental phenomenon in inflammation is the loss of endothelial barrier function, in which the opening of endothelial cell junctions plays a central role. However, the molecular mechanisms that ultimately open the cell junctions are largely unknown. |
|
Stockinger P, Maître JL, Heisenberg CP
|
Defective neuroepithelial cell cohesion affects tangential branchiomotor neuron migration in the zebrafish neural tube.
|
Development 2011 Nov 28;138(21):4673-83
|
|
Developmental Biology
|

|
21965614 |
|
Facial branchiomotor neurons (FBMNs) in zebrafish and mouse embryonic hindbrain undergo a characteristic tangential migration from rhombomere (r) 4, where they are born, to r6/7. Cohesion among neuroepithelial cells (NCs) has been suggested to function in FBMN migration by inhibiting FBMNs positioned in the basal neuroepithelium such that they move apically between NCs towards the midline of the neuroepithelium instead of tangentially along the basal side of the neuroepithelium towards r6/7. However, direct experimental evaluation of this hypothesis is still lacking. Here, we have used a combination of biophysical cell adhesion measurements and high-resolution time-lapse microscopy to determine the role of NC cohesion in FBMN migration. We show that reducing NC cohesion by interfering with Cadherin 2 (Cdh2) activity results in FBMNs positioned at the basal side of the neuroepithelium moving apically towards the neural tube midline instead of tangentially towards r6/7. In embryos with strongly reduced NC cohesion, ectopic apical FBMN movement frequently results in fusion of the bilateral FBMN clusters over the apical midline of the neural tube. By contrast, reducing cohesion among FBMNs by interfering with Contactin 2 (Cntn2) expression in these cells has little effect on apical FBMN movement, but reduces the fusion of the bilateral FBMN clusters in embryos with strongly diminished NC cohesion. These data provide direct experimental evidence that NC cohesion functions in tangential FBMN migration by restricting their apical movement. |
|
Kaiser HJ, Surma MA, Mayer F, Levental I, Grzybek M, Klemm RW, Da Cruz S, Meisinger C, Müller V, Simons K, Lingwood D
|
Molecular convergence of bacterial and eukaryotic surface order.
|
J. Biol. Chem. 2011 Nov 25;286(47):40631-7
|
|
Cell Biology
|
|
21965671 |
|
The conservation of fluidity is a theme common to all cell membranes. In this study, an analysis of lipid packing was conducted via C-laurdan spectroscopy of cell surface membranes prepared from representative species of Bacteria and Eukarya. We found that despite their radical differences in composition (namely the presence and absence of membrane-rigidifying sterol) the membrane order of all taxa converges on a remarkably similar level. To understand how this similarity is constructed, we reconstituted membranes with either bacterial or eukaryotic components. We found that transmembrane segments of proteins have an important role in buffering lipid-mediated packing. This buffering ensures that sterol-free and sterol-containing membranes exhibit similar barrier properties. |
|
Gerisch G, Ecke M, Wischnewski D, Schroth-Diez B
|
Different modes of state transitions determine pattern in the Phosphatidylinositide-Actin system.
|
BMC Cell Biol. 2011 Oct 07;12:42
|
|
Cell Biology
|

|
21982379 |
|
In a motile polarized cell the actin system is differentiated to allow protrusion at the front and retraction at the tail. This differentiation is linked to the phosphoinositide pattern in the plasma membrane. In the highly motile Dictyostelium cells studied here, the front is dominated by PI3-kinases producing PI(3,4,5)tris-phosphate (PIP3), the tail by the PI3-phosphatase PTEN that hydrolyses PIP3 to PI(4,5)bis-phosphate. To study de-novo cell polarization, we first depolymerized actin and subsequently recorded the spontaneous reorganization of actin patterns in relation to PTEN. |
|
Aleksandrowicz P, Marzi A, Biedenkopf N, Beimforde N, Becker S, Hoenen T, Feldmann H, Schnittler HJ
|
Ebola virus enters host cells by macropinocytosis and clathrin-mediated endocytosis.
|
J. Infect. Dis. 2011 Nov;204 Suppl 3:S957-67
|
|
Medical Biology
|

|
21987776 |
|
Virus entry into host cells is the first step of infection and a crucial determinant of pathogenicity. Here we show that Ebola virus-like particles (EBOV-VLPs) composed of the glycoprotein GP(1,2) and the matrix protein VP40 use macropinocytosis and clathrin-mediated endocytosis to enter cells. EBOV-VLPs applied to host cells induced actin-driven ruffling and enhanced FITC-dextran uptake, which indicated macropinocytosis as the main entry mechanism. This was further supported by inhibition of entry through inhibitors of actin polymerization (latrunculin A), Na(+)/H(+)-exchanger (EIPA), and PI3-kinase (wortmannin). A fraction of EBOV-VLPs, however, colocalized with clathrin heavy chain (CHC), and VLP uptake was reduced by CHC small interfering RNA transfection and expression of the dominant negative dynamin II-K44A mutant. In contrast, we found no evidence that EBOV-VLPs enter cells via caveolae. This work identifies macropinocytosis as the major, and clathrin-dependent endocytosis as an alternative, entry route for EBOV particles. Therefore, EBOV seems to utilize different entry pathways depending on both cell type and virus particle size. |
|
Kroehne V, Freudenreich D, Hans S, Kaslin J, Brand M
|
Regeneration of the adult zebrafish brain from neurogenic radial glia-type progenitors.
|
Development 2011 Nov 17;138(22):4831-41
|
- EMF & Histo CMCB
- LMF CMCB
|
Developmental Biology
|

|
22007133 |
|
Severe traumatic injury to the adult mammalian CNS leads to life-long loss of function. By contrast, several non-mammalian vertebrate species, including adult zebrafish, have a remarkable ability to regenerate injured organs, including the CNS. However, the cellular and molecular mechanisms that enable or prevent CNS regeneration are largely unknown. To study brain regeneration mechanisms in adult zebrafish, we developed a traumatic lesion assay, analyzed cellular reactions to injury and show that adult zebrafish can efficiently regenerate brain lesions and lack permanent glial scarring. Using Cre-loxP-based genetic lineage-tracing, we demonstrate that her4.1-positive ventricular radial glia progenitor cells react to injury, proliferate and generate neuroblasts that migrate to the lesion site. The newly generated neurons survive for more than 3 months, are decorated with synaptic contacts and express mature neuronal markers. Thus, regeneration after traumatic lesion of the adult zebrafish brain occurs efficiently from radial glia-type stem/progenitor cells. |
|
Ettinger AW, Wilsch-Bräuninger M, Marzesco AM, Bickle M, Lohmann A, Maliga Z, Karbanová J, Corbeil D, Hyman AA, Huttner WB
|
Proliferating versus differentiating stem and cancer cells exhibit distinct midbody-release behaviour.
|
Nat Commun 2011 Oct 18;2:503
|
- EMF MPI-CBG
- LMF MPI-CBG
- Screening MPI-CBG
|
Neurobiology
|

|
22009035 |
|
The central portion of the midbody, a cytoplasmic bridge between nascent daughter cells at the end of cell division, has generally been thought to be retained by one of the daughter cells, but has, recently, also been shown to be released into the extracellular space. The significance of midbody-retention versus -release is unknown. Here we show, by quantitatively analysing midbody-fate in various cell lines under different growth conditions, that the extent of midbody-release is significantly greater in stem cells than cancer-derived cells. Induction of cell differentiation is accompanied by an increase in midbody-release. Knockdown of the endosomal sorting complex required for transport family members, Alix and tumour-suppressor gene 101, or of their interaction partner, centrosomal protein 55, impairs midbody-release, suggesting mechanistic similarities to abscission. Cells with such impaired midbody-release exhibit enhanced responsiveness to a differentiation stimulus. Taken together, midbody-release emerges as a characteristic feature of cells capable of differentiation. |
|
Goehring NW, Trong PK, Bois JS, Chowdhury D, Nicola EM, Hyman AA, Grill SW
|
Polarization of PAR proteins by advective triggering of a pattern-forming system.
|
Science 2011 Nov 25;334(6059):1137-41
|
|
Cell Biology
|

|
22021673 |
|
In the Caenorhabditis elegans zygote, a conserved network of partitioning-defective (PAR) polarity proteins segregates into an anterior and a posterior domain, facilitated by flows of the cortical actomyosin meshwork. The physical mechanisms by which stable asymmetric PAR distributions arise from transient cortical flows remain unclear. We present evidence that PAR polarity arises from coupling of advective transport by the flowing cell cortex to a multistable PAR reaction-diffusion system. By inducing transient PAR segregation, advection serves as a mechanical trigger for the formation of a PAR pattern within an otherwise stably unpolarized system. We suggest that passive advective transport in an active and flowing material may be a general mechanism for mechanochemical pattern formation in developmental systems. |
|
Muschalik N, Knust E
|
Increased levels of the cytoplasmic domain of Crumbs repolarise developing Drosophila photoreceptors.
|
J. Cell. Sci. 2011 Nov 1;124(Pt 21):3715-25
|
|
Developmental Biology
|

|
22025631 |
|
Photoreceptor morphogenesis in Drosophila requires remodelling of apico-basal polarity and adherens junctions (AJs), and includes cell shape changes, as well as differentiation and expansion of the apical membrane. The evolutionarily conserved transmembrane protein Crumbs (Crb) organises an apical membrane-associated protein complex that controls photoreceptor morphogenesis. Expression of the small cytoplasmic domain of Crb in crb mutant photoreceptor cells (PRCs) rescues the crb mutant phenotype to the same extent as the full-length protein. Here, we show that overexpression of the membrane-tethered cytoplasmic domain of Crb in otherwise wild-type photoreceptor cells has major effects on polarity and morphogenesis. Whereas early expression causes severe abnormalities in apico-basal polarity and ommatidial integrity, expression at later stages affects the shape and positioning of AJs. This result supports the importance of Crb for junctional remodelling during morphogenetic changes. The most pronounced phenotype observed upon early expression is the formation of ectopic apical membrane domains, which often develop into a complete second apical pole, including ectopic AJs. Induction of this phenotype requires members of the Par protein network. These data point to a close integration of the Crb complex and Par proteins during photoreceptor morphogenesis and underscore the role of Crb as an apical determinant. |
|
Leung L, Klopper AV, Grill SW, Harris WA, Norden C
|
Apical migration of nuclei during G2 is a prerequisite for all nuclear motion in zebrafish neuroepithelia.
|
Development 2011 Nov;138(22):5003-13
|
|
Developmental Biology
|

|
22028032 |
|
Nuclei in the proliferative pseudostratified epithelia of vastly different organisms exhibit a characteristic dynamics - the so-called interkinetic nuclear migration (IKNM). Although these movements are thought to be intimately tied to the cell cycle, little is known about the relationship between IKNM and distinct phases of the cell cycle and the role that this association plays in ensuring balanced proliferation and subsequent differentiation. Here, we perform a quantitative analysis of modes of nuclear migration during the cell cycle using a marker that enables the first unequivocal differentiation of all four phases in proliferating neuroepithelial cells in vivo. In zebrafish neuroepithelia, nuclei spend the majority of the cell cycle in S phase, less time in G1, with G2 and M being noticeably shorter still in comparison. Correlating cell cycle phases with nuclear movements shows that IKNM comprises rapid apical nuclear migration during G2 phase and stochastic nuclear motion during G1 and S phases. The rapid apical migration coincides with the onset of G2, during which we find basal actomyosin accumulation. Inhibiting the transition from G2 to M phase induces a complete stalling of nuclei, indicating that IKNM and cell cycle continuation cannot be uncoupled and that progression from G2 to M is a prerequisite for rapid apical migration. Taken together, these results suggest that IKNM involves an actomyosin-driven contraction of cytoplasm basal to the nucleus during G2, and that the stochastic nuclear movements observed in other phases arise passively due to apical migration in neighboring cells. |
|
Pfennig F, Kurth T, Meissner S, Standke A, Hoppe M, Zieschang F, Reitmayer C, Göbel A, Kretzschmar G, Gutzeit HO
|
The social status of the male Nile tilapia (Oreochromis niloticus) influences testis structure and gene expression.
|
Reproduction 2012 Jan 1;143(1):71-84
|
|
Developmental Biology
|

|
22031714 |
|
Dominant and territorial behaviour are known social phenomena in cichlids and social stress influences reproduction and growth. The gonadotropic hormones trigger spermatogenesis and subordinate males have typically lower levels of gonadotropins than dominant males. In this study, we compared testis morphology and gene expression of dominant and subordinate Nile tilapia males (d- and s-males) in socially stable communities. The d-males had the highest gonadosomatic index but they were not the largest animals in the majority of studied cases. Long-term d-males showed large groups of Leydig cells and hyperplasia of the tunica albuginea due to numerous cytochrome-P450-11?-hydroxylase (Cyp11b) expressing myoid cells. Increased Cyp11b expression in d-males was reflected by elevated 11-ketotestosterone plasma values. However, immunofluorescence microscopy and expression analysis of selected genes revealed that most s-males conserved their capability for spermatogenesis and are, therefore, ready for reproduction when the social environment changes. Moreover, in s-males gene expression analysis by quantitative RT-PCR showed increased transcript levels for germ line-specific genes (vasa, sox2 and dmc1) and Sertoli-specific genes (amh, amhrII and dmrt1) whereas gene expression of key factors for steroid production (sf1 and cyp11b) were reduced. The Nile tilapia is a promising model to study social cues and gonadotropic signals on testis development in vertebrates. |
|
Torsney-Weir T, Saad A, Möller T, Weber B, Hege HC, Verbavatz JM, Bergner S
|
Tuner: principled parameter finding for image segmentation algorithms using visual response surface exploration.
|
IEEE Trans Vis Comput Graph 2011 Dec;17(12):1892-901
|
|
Image Processing
|

|
22034306 |
|
In this paper we address the difficult problem of parameter-finding in image segmentation. We replace a tedious manual process that is often based on guess-work and luck by a principled approach that systematically explores the parameter space. Our core idea is the following two-stage technique: We start with a sparse sampling of the parameter space and apply a statistical model to estimate the response of the segmentation algorithm. The statistical model incorporates a model of uncertainty of the estimation which we use in conjunction with the actual estimate in (visually) guiding the user towards areas that need refinement by placing additional sample points. In the second stage the user navigates through the parameter space in order to determine areas where the response value (goodness of segmentation) is high. In our exploration we rely on existing ground-truth images in order to evaluate the "goodness" of an image segmentation technique. We evaluate its usefulness by demonstrating this technique on two image segmentation algorithms: a three parameter model to detect microtubules in electron tomograms and an eight parameter model to identify functional regions in dynamic Positron Emission Tomography scans. |
|
Kauert DJ, Kurth T, Liedl T, Seidel R
|
Direct mechanical measurements reveal the material properties of three-dimensional DNA origami.
|
Nano Lett. 2011 Dec 14;11(12):5558-63
|
|
Biophysics
|

|
22047401 |
|
The application of three-dimensional DNA origami objects as rigid mechanical mediators or force sensing elements requires detailed knowledge about their complex mechanical properties. Using magnetic tweezers, we directly measure the bending and torsional rigidities of four- and six-helix bundles assembled by this technique. Compared to duplex DNA, we find the bending rigidities to be greatly increased while the torsional rigidities are only moderately augmented. We present a mechanical model explicitly including the crossovers between the individual helices in the origami structure that reproduces the experimentally observed behavior. Our results provide an important basis for the future application of 3D DNA origami in nanomechanics. |
|
Jing D, Wobus M, Poitz DM, Bornhäuser M, Ehninger G, Ordemann R
|
Oxygen tension plays a critical role in the hematopoietic microenvironment in vitro.
|
Haematologica 2012 Mar 04;97(3):331-9
|
|
Medical Biology
|

|
22058205 |
|
In the bone marrow mesenchymal stromal cells and osteoblasts form functional niches for hematopoietic stem and progenitor cells. This microenvironment can be partially mimicked using in vitro co-culture systems. In this study, we examined the oxygen tension in three distinct compartments in a co-culture system of purified CD34(+) cells and mesenchymal stromal cells with regard to different spatial localizations. |
|
Oppel F, Müller N, Schackert G, Hendruschk S, Martin D, Geiger KD, Temme A
|
SOX2-RNAi attenuates S-phase entry and induces RhoA-dependent switch to protease-independent amoeboid migration in human glioma cells.
|
Mol. Cancer 2011 Nov 09;10:137
|
|
Medical Biology
|

|
22070920 |
|
SOX2, a high mobility group (HMG)-box containing transcription factor, is a key regulator during development of the nervous system and a persistent marker of neural stem cells. Recent studies suggested a role of SOX2 in tumor progression. In our previous work we detected SOX2 in glioma cells and glioblastoma specimens. Herein, we aim to explore the role of SOX2 for glioma malignancy in particular its role in cell proliferation and migration. |
|
Kizil C, Brand M
|
Cerebroventricular microinjection (CVMI) into adult zebrafish brain is an efficient misexpression method for forebrain ventricular cells.
|
PLoS ONE 2011 Nov 04;6(11):e27395
|
|
Imaging Technologies Development
|

|
22076157 |
|
The teleost fish Danio rerio (zebrafish) has a remarkable ability to generate newborn neurons in its brain at adult stages of its lifespan-a process called adult neurogenesis. This ability relies on proliferating ventricular progenitors and is in striking contrast to mammalian brains that have rather restricted capacity for adult neurogenesis. Therefore, investigating the zebrafish brain can help not only to elucidate the molecular mechanisms of widespread adult neurogenesis in a vertebrate species, but also to design therapies in humans with what we learn from this teleost. Yet, understanding the cellular behavior and molecular programs underlying different biological processes in the adult zebrafish brain requires techniques that allow manipulation of gene function. As a complementary method to the currently used misexpression techniques in zebrafish, such as transgenic approaches or electroporation-based delivery of DNA, we devised a cerebroventricular microinjection (CVMI)-assisted knockdown protocol that relies on vivo morpholino oligonucleotides, which do not require electroporation for cellular uptake. This rapid method allows uniform and efficient knockdown of genes in the ventricular cells of the zebrafish brain, which contain the neurogenic progenitors. We also provide data on the use of CVMI for growth factor administration to the brain--in our case FGF8, which modulates the proliferation rate of the ventricular cells. In this paper, we describe the CVMI method and discuss its potential uses in zebrafish. |
|
Kurth T, Weiche S, Vorkel D, Kretschmar S, Menge A
|
Histology of plastic embedded amphibian embryos and larvae.
|
Genesis 2012 Mar 27;50(3):235-50
|
- EMF & Histo CMCB
- EMF MPI-CBG
|
Imaging Technologies Development
|

|
22083609 |
|
Amphibians including the South African clawed frog Xenopus laevis, its close relative Xenopus tropicalis, and the Mexican axolotl (Ambystoma mexicanum) are important vertebrate models for cell biology, development, and regeneration. For the analysis of embryos and larva with altered gene expression in gain-of-function or loss-of-function studies histology is increasingly important. Here, we discuss plastic or resin embedding of embryos as valuable alternatives to conventional paraffin embedding. For example, microwave-assisted tissue processing, combined with embedding in the glycol methacrylate Technovit 7100, is a fast, simple, and reliable method to obtain state-of-the-art histology with high resolution of cellular details in less than a day. Microwave-processed samples embedded in Epon 812 are also useful for transmission electron microscopy. Finally, Technovit-embedded samples are well suited for serial section analysis of embryos labeled either by whole-mount immunofluorescence, or with tracers such as GFP or fluorescent dextrans. Therefore, plastic embedding offers a versatile alternative to paraffin embedding for routine histology and immunocytochemistry of amphibian embryos. |
|
Wilsch-Bräuninger M, Peters J, Paridaen JT, Huttner WB
|
Basolateral rather than apical primary cilia on neuroepithelial cells committed to delamination.
|
Development 2012 Jan 17;139(1):95-105
|
|
Neurobiology
|

|
22096071 |
|
Delamination of neural progenitors from the apical adherens junction belt of the neuroepithelium is a hallmark of cerebral cortex development and evolution. Specific cell biological processes preceding this delamination are largely unknown. Here, we identify a novel, pre-delamination state of neuroepithelial cells in mouse embryonic neocortex. Specifically, in a subpopulation of neuroepithelial cells that, like all others, exhibit apical-basal polarity and apical adherens junctions, the re-establishing of the primary cilium after mitosis occurs at the basolateral rather than the apical plasma membrane. Neuroepithelial cells carrying basolateral primary cilia appear at the onset of cortical neurogenesis, increase in abundance with its progression, selectively express the basal (intermediate) progenitor marker Tbr2, and eventually delaminate from the apical adherens junction belt to become basal progenitors, translocating their nucleus from the ventricular to the subventricular zone. Overexpression of insulinoma-associated 1, a transcription factor known to promote the generation of basal progenitors, increases the proportion of basolateral cilia. Basolateral cilia in cells delaminating from the apical adherens junction belt are preferentially found near spot-like adherens junctions, suggesting that the latter provide positional cues to basolateral ciliogenesis. We conclude that re-establishing a basolateral primary cilium constitutes the first known cell biological feature preceding neural progenitor delamination. |
|
Kagermeier-Schenk B, Wehner D, Ozhan-Kizil G, Yamamoto H, Li J, Kirchner K, Hoffmann C, Stern P, Kikuchi A, Schambony A, Weidinger G
|
Waif1/5T4 inhibits Wnt/β-catenin signaling and activates noncanonical Wnt pathways by modifying LRP6 subcellular localization.
|
Dev. Cell 2011 Dec 13;21(6):1129-43
|
|
Developmental Biology
|

|
22100263 |
|
Wnt proteins can activate distinct signaling pathways, but little is known about the mechanisms regulating pathway selection. Here we show that the metastasis-associated transmembrane protein Wnt-activated inhibitory factor 1 (Waif1/5T4) interferes with Wnt/β-catenin signaling and concomitantly activates noncanonical Wnt pathways. Waif1 inhibits β-catenin signaling in zebrafish and Xenopus embryos as well as in mammalian cells, and zebrafish waif1a acts as a direct feedback inhibitor of wnt8-mediated mesoderm and neuroectoderm patterning during zebrafish gastrulation. Waif1a binds to the Wnt coreceptor LRP6 and inhibits Wnt-induced LRP6 internalization into endocytic vesicles, a process that is required for pathway activation. Thus, Waif1a modifies Wnt/β-catenin signaling by regulating LRP6 subcellular localization. In addition, Waif1a enhances β-catenin-independent Wnt signaling in zebrafish embryos and Xenopus explants by promoting a noncanonical function of Dickkopf1. These results suggest that Waif1 modulates pathway selection in Wnt-receiving cells. |
|
Knobloch D, Ostermann K, Rödel G
|
Production, secretion, and cell surface display of recombinant Sporosarcina ureae S-layer fusion proteins in Bacillus megaterium.
|
Appl. Environ. Microbiol. 2012 Jan 18;78(2):560-7
|
|
Cell Biology
|

|
22101038 |
|
Monomolecular crystalline bacterial cell surface layers (S-layers) have broad application potential in nanobiotechnology due to their ability to generate functional supramolecular structures. Here, we report that Bacillus megaterium is an excellent host organism for the heterologous expression and efficient secretion of hemagglutinin (HA) epitope-tagged versions of the S-layer protein SslA from Sporosarcina ureae ATCC 13881. Three chimeric proteins were constructed, comprising the precursor, C-terminally truncated, and N- and C-terminally truncated forms of the S-layer SslA protein tagged with the human influenza hemagglutinin epitope. For secretion of fusion proteins, the open reading frames were cloned into the Escherichia coli-Bacillus megaterium shuttle vector pHIS1525. After transformation of the respective plasmids into Bacillus megaterium protoplasts, the recombinant genes were successfully expressed and the proteins were secreted into the growth medium. The isolated S-layer proteins are able to assemble in vitro into highly ordered, crystalline, sheetlike structures with the fused HA tag accessible to antibody. We further show by fluorescent labeling that the secreted S-layer fusion proteins are also clustered on the cell envelope of Bacillus megaterium, indicating that the cell surface can serve in vivo as a nucleation point for crystallization. Thus, this system can be used as a display system that allows the dense and periodic presentation of S-layer proteins or the fused tags. |
|
Pocha SM, Shevchenko A, Knust E
|
Crumbs regulates rhodopsin transport by interacting with and stabilizing myosin V.
|
J. Cell Biol. 2011 Nov 28;195(5):827-38
|
|
Cell Biology
|

|
22105348 |
|
The evolutionarily conserved Crumbs (Crb) complex is crucial for photoreceptor morphogenesis and homeostasis. Loss of Crb results in light-dependent retinal degeneration, which is prevented by feeding mutant flies carotenoid-deficient medium. This suggests a defect in rhodopsin 1 (Rh1) processing, transport, and/or signaling, causing degeneration; however, the molecular mechanism of this remained elusive. In this paper, we show that myosin V (MyoV) coimmunoprecipitated with the Crb complex and that loss of crb led to severe reduction in MyoV levels, which could be rescued by proteasomal inhibition. Loss of MyoV in crb mutant photoreceptors was accompanied by defective transport of the MyoV cargo Rh1 to the light-sensing organelle, the rhabdomere. This resulted in an age-dependent accumulation of Rh1 in the photoreceptor cell (PRC) body, a well-documented trigger of degeneration. We conclude that Crb protects against degeneration by interacting with and stabilizing MyoV, thereby ensuring correct Rh1 trafficking. Our data provide, for the first time, a molecular mechanism for the light-dependent degeneration of PRCs observed in crb mutant retinas. |
|
Kelava I, Reillo I, Murayama AY, Kalinka AT, Stenzel D, Tomancak P, Matsuzaki F, Lebrand C, Sasaki E, Schwamborn JC, Okano H, Huttner WB, Borrell V
|
Abundant occurrence of basal radial glia in the subventricular zone of embryonic neocortex of a lissencephalic primate, the common marmoset Callithrix jacchus.
|
Cereb. Cortex 2012 Feb 23;22(2):469-81
|
|
Cell Biology
|

|
22114084 |
|
Subventricular zone (SVZ) progenitors are a hallmark of the developing neocortex. Recent studies described a novel type of SVZ progenitor that retains a basal process at mitosis, sustains expression of radial glial markers, and is capable of self-renewal. These progenitors, referred to here as basal radial glia (bRG), occur at high relative abundance in the SVZ of gyrencephalic primates (human) and nonprimates (ferret) but not lissencephalic rodents (mouse). Here, we analyzed the occurrence of bRG cells in the embryonic neocortex of the common marmoset Callithrix jacchus, a near-lissencephalic primate. bRG cells, expressing Pax6, Sox2 (but not Tbr2), glutamate aspartate transporter, and glial fibrillary acidic protein and retaining a basal process at mitosis, occur at similar relative abundance in the marmoset SVZ as in human and ferret. The proportion of progenitors in M-phase was lower in embryonic marmoset than developing ferret neocortex, raising the possibility of a longer cell cycle. Fitting the gyrification indices of 26 anthropoid species to an evolutionary model suggested that the marmoset evolved from a gyrencephalic ancestor. Our results suggest that a high relative abundance of bRG cells may be necessary, but is not sufficient, for gyrencephaly and that the marmoset's lissencephaly evolved secondarily by changing progenitor parameters other than progenitor type. |
|
Bird AW, Erler A, Fu J, Hériché JK, Maresca M, Zhang Y, Hyman AA, Stewart AF
|
High-efficiency counterselection recombineering for site-directed mutagenesis in bacterial artificial chromosomes.
|
Nat. Methods 2012 Jan 04;9(1):103-9
|
|
Cell Biology
|

|
22138824 |
|
Whereas bacterial artificial chromosomes (BACs) offer many advantages in studies of gene and protein function, generation of seamless, precisely mutated BACs has been difficult. Here we describe a counterselection-based recombineering method and its accompanying reagents. After identifying intramolecular recombination as the major problem in counterselection, we built a strategy to reduce these unwanted events by expressing Red? alone at the crucial step. We enhanced this method by using phosphothioated oligonucleotides, using a sequence-altered rpsL counterselection gene and developing online software for oligonucleotide design. We illustrated this method by generating transgenic mammalian cell lines carrying small interfering RNA-resistant and point-mutated BAC transgenes. Using this approach, we generated mutated TACC3 transgenes to identify phosphorylation-specific spindle defects after knockdown of endogenous TACC3 expression. Our results highlight the complementary use of precisely mutated BAC transgenes and RNA interference in the study of cell biology at physiological expression levels and regulation. |
|
Taverna E, Haffner C, Pepperkok R, Huttner WB
|
A new approach to manipulate the fate of single neural stem cells in tissue.
|
Nat. Neurosci. 2012 Feb 18;15(2):329-37
|
|
Neurobiology
|

|
22179113 |
|
A challenge in the field of neural stem cell biology is the mechanistic dissection of single stem cell behavior in tissue. Although such behavior can be tracked by sophisticated imaging techniques, current methods of genetic manipulation do not allow researchers to change the level of a defined gene product on a truly acute time scale and are limited to very few genes at a time. To overcome these limitations, we established microinjection of neuroepithelial/radial glial cells (apical progenitors) in organotypic slice culture of embryonic mouse brain. Microinjected apical progenitors showed cell cycle parameters that were indistinguishable to apical progenitors in utero, underwent self-renewing divisions and generated neurons. Microinjection of single genes, recombinant proteins or complex mixtures of RNA was found to elicit acute and defined changes in apical progenitor behavior and progeny fate. Thus, apical progenitor microinjection provides a new approach to acutely manipulating single neural stem and progenitor cells in tissue. |
|
Weber B, Greenan G, Prohaska S, Baum D, Hege HC, Müller-Reichert T, Hyman AA, Verbavatz JM
|
Automated tracing of microtubules in electron tomograms of plastic embedded samples of Caenorhabditis elegans embryos.
|
J. Struct. Biol. 2012 May 13;178(2):129-38
|
- EMF MPI-CBG
- LMF & EMF CFCI
|
Imaging Technologies Development
|

|
22182731 |
|
The ability to rapidly assess microtubule number in 3D image stacks from electron tomograms is essential for collecting statistically meaningful data sets. Here we implement microtubule tracing using 3D template matching. We evaluate our results by comparing the automatically traced centerlines to manual tracings in a large number of electron tomograms of the centrosome of the early Caenorhabditis elegans embryo. Furthermore, we give a qualitative description of the tracing results for three other types of samples. For dual-axis tomograms, the automatic tracing yields 4% false negatives and 8% false positives on average. For single-axis tomograms, the accuracy of tracing is lower (16% false negatives and 14% false positives) due to the missing wedge in electron tomography. We also implemented an editor specifically designed for correcting the automatic tracing. Besides, this editor can be used for annotating microtubules. The automatic tracing together with a manual correction significantly reduces the amount of manual labor for tracing microtubule centerlines so that large-scale analysis of microtubule network properties becomes feasible. |
|
Stewart MP, Toyoda Y, Hyman AA, Müller DJ
|
Tracking mechanics and volume of globular cells with atomic force microscopy using a constant-height clamp.
|
Nat Protoc 2012 Jan 05;7(1):143-54
|
|
Biophysics
|

|
22222789 |
|
To understand the role of physical forces at a cellular level, it is necessary to track mechanical properties during cellular processes. Here we present a protocol that uses flat atomic force microscopy (AFM) cantilevers clamped at constant height, and light microscopy to measure the resistance force, mechanical stress and volume of globular animal cells under compression. We describe the AFM and cantilever setup, live cell culture in the AFM, how to ensure stability of AFM measurements during medium perfusion, integration of optical microscopy to measure parameters such as volume and track intracellular dynamics, and interpretation of the physical parameters measured. Although we use this protocol on trypsinized interphase and mitotic HeLa cells, it can also be applied to other cells with a relatively globular shape, especially animal cells in a low-adhesive environment. After a short setup phase, the protocol can be used to investigate approximately one cell per hour. |
|
Gerl MJ, Sampaio JL, Urban S, Kalvodova L, Verbavatz JM, Binnington B, Lindemann D, Lingwood CA, Shevchenko A, Schroeder C, Simons K
|
Quantitative analysis of the lipidomes of the influenza virus envelope and MDCK cell apical membrane.
|
J. Cell Biol. 2012 Jan 23;196(2):213-21
|
|
Cell Biology
|

|
22249292 |
|
The influenza virus (IFV) acquires its envelope by budding from host cell plasma membranes. Using quantitative shotgun mass spectrometry, we determined the lipidomes of the host Madin-Darby canine kidney cell, its apical membrane, and the IFV budding from it. We found the apical membrane to be enriched in sphingolipids (SPs) and cholesterol, whereas glycerophospholipids were reduced, and storage lipids were depleted compared with the whole-cell membranes. The virus membrane exhibited a further enrichment of SPs and cholesterol compared with the donor membrane at the expense of phosphatidylcholines. Our data are consistent with and extend existing models of membrane raft-based biogenesis of the apical membrane and IFV envelope. |
|
Fava E, Dehghany J, Ouwendijk J, Müller A, Niederlein A, Verkade P, Meyer-Hermann M, Solimena M
|
Novel standards in the measurement of rat insulin granules combining electron microscopy, high-content image analysis and in silico modelling.
|
Diabetologia 2012 Apr 18;55(4):1013-23
|
- EMF & Histo CMCB
- EMF MPI-CBG
|
Imaging Technologies Development
|

|
22252472 |
|
Knowledge of number, size and content of insulin secretory granules is pivotal for understanding the physiology of pancreatic beta cells. Here we re-evaluated key structural features of rat beta cells, including insulin granule size, number and distribution as well as cell size. |
|
O'Toole E, Greenan G, Lange KI, Srayko M, Müller-Reichert T
|
The role of γ-tubulin in centrosomal microtubule organization.
|
PLoS ONE 2012 Jan 10;7(1):e29795
|
- EMF MPI-CBG
- LMF MPI-CBG
- LMF & EMF CFCI
|
Cell Biology
|

|
22253783 |
|
As part of a multi-subunit ring complex, γ-tubulin has been shown to promote microtubule nucleation both in vitro and in vivo, and the structural properties of the complex suggest that it also seals the minus ends of the polymers with a conical cap. Cells depleted of γ-tubulin, however, still display many microtubules that participate in mitotic spindle assembly, suggesting that γ-tubulin is not absolutely required for microtubule nucleation in vivo, and raising questions about the function of the minus end cap. Here, we assessed the role of γ-tubulin in centrosomal microtubule organisation using three-dimensional reconstructions of γ-tubulin-depleted C. elegans embryos. We found that microtubule minus-end capping and the PCM component SPD-5 are both essential for the proper placement of microtubules in the centrosome. Our results further suggest that γ-tubulin and SPD-5 limit microtubule polymerization within the centrosome core, and we propose a model for how abnormal microtubule organization at the centrosome could indirectly affect centriole structure and daughter centriole replication. |
|
Hochmann S, Kaslin J, Hans S, Weber A, Machate A, Geffarth M, Funk RH, Brand M
|
Fgf signaling is required for photoreceptor maintenance in the adult zebrafish retina.
|
PLoS ONE 2012 Jan 26;7(1):e30365
|
- EMF & Histo CMCB
- LMF CMCB
|
Developmental Biology
|

|
22291943 |
|
Fibroblast growth factors (Fgf) are secreted signaling molecules that have mitogenic, patterning, neurotrophic and angiogenic properties. Their importance during embryonic development in patterning and morphogenesis of the vertebrate eye is well known, but less is known about the role of Fgfs in the adult vertebrate retina. To address Fgf function in adult retina, we determined the spatial distribution of components of the Fgf signaling pathway in the adult zebrafish retina. We detected differential expression of Fgf receptors, ligands and downstream Fgf targets within specific retinal layers. Furthermore, we blocked Fgf signaling in the retina, by expressing a dominant negative variant of Fgf receptor 1 conditionally in transgenic animals. After blocking Fgf signaling we observe a fast and progressive photoreceptor degeneration and disorganization of retinal tissue, coupled with cell death in the outer nuclear layer. Following the degeneration of photoreceptors, a profound regeneration response is triggered that starts with proliferation in the inner nuclear layer. Ultimately, rod and cone photoreceptors are regenerated completely. Our study reveals the requirement of Fgf signaling to maintain photoreceptors and for proliferation during regeneration in the adult zebrafish retina. |
|
Jgamadze D, Bergen J, Stone D, Jang JH, Schaffer DV, Isacoff EY, Pautot S
|
Colloids as mobile substrates for the implantation and integration of differentiated neurons into the mammalian brain.
|
PLoS ONE 2012 Jan 25;7(1):e30293
|
|
Neurobiology
|

|
22295079 |
|
Neuronal degeneration and the deterioration of neuronal communication lie at the origin of many neuronal disorders, and there have been major efforts to develop cell replacement therapies for treating such diseases. One challenge, however, is that differentiated cells are challenging to transplant due to their sensitivity both to being uprooted from their cell culture growth support and to shear forces inherent in the implantation process. Here, we describe an approach to address these problems. We demonstrate that rat hippocampal neurons can be grown on colloidal particles or beads, matured and even transfected in vitro, and subsequently transplanted while adhered to the beads into the young adult rat hippocampus. The transplanted cells have a 76% cell survival rate one week post-surgery. At this time, most transplanted neurons have left their beads and elaborated long processes, similar to the host neurons. Additionally, the transplanted cells distribute uniformly across the host hippocampus. Expression of a fluorescent protein and the light-gated glutamate receptor in the transplanted neurons enabled them to be driven to fire by remote optical control. At 1-2 weeks after transplantation, calcium imaging of host brain slice shows that optical excitation of the transplanted neurons elicits activity in nearby host neurons, indicating the formation of functional transplant-host synaptic connections. After 6 months, the transplanted cell survival and overall cell distribution remained unchanged, suggesting that cells are functionally integrated. This approach, which could be extended to other cell classes such as neural stem cells and other regions of the brain, offers promising prospects for neuronal circuit repair via transplantation of in vitro differentiated, genetically engineered neurons. |
|
Chakraborty D, Kappei D, Theis M, Nitzsche A, Ding L, Paszkowski-Rogacz M, Surendranath V, Berger N, Schulz H, Saar K, Hubner N, Buchholz F
|
Combined RNAi and localization for functionally dissecting long noncoding RNAs.
|
Nat. Methods 2012 Apr 12;9(4):360-2
|
|
Cell Biology
|

|
22327834 |
|
Whereas methods to comprehensively study cellular roles of protein-coding genes are available, techniques to systematically investigate long noncoding RNAs (lncRNAs), which have been implicated in diverse biological pathways, are limited. Here we report combined knockdown and localization analysis of noncoding RNAs (c-KLAN) that merges functional characterization and localization approaches to study lncRNAs. Using this technique we identified transcripts that regulate mouse embryonic stem cell identity. |
|
Luzzietti N, Knappe S, Richter I, Seidel R
|
Nicking enzyme-based internal labeling of DNA at multiple loci.
|
Nat Protoc 2012 Apr 08;7(4):643-53
|
|
Cell Biology
|

|
22402634 |
|
The labeling of biomolecules has become standard practice in molecular biosciences. Modifications are used for detection, sorting and isolation of small molecules, complexes and entire cells. We have recently reported a method for introducing internal chemical and structural modifications into kbp-sized DNA target substrates that are frequently used in single-molecule experiments. It makes use of nicking enzymes that create single-stranded DNA gaps, which can be subsequently filled with labeled oligonucleotides. Here we provide a detailed protocol and further expand this method. We show that modifications can be introduced at distant loci within one molecule in a simple one-pot reaction. In addition, we achieve labeling on both strands at a specific locus, as demonstrated by Förster resonance energy transfer (FRET) experiments. The protocol requires an initial cloning of the target substrate (3-5 d), whereas the labeling itself takes 4-6 h. More elaborate purification and verification of label incorporation requires 2 h for each method. |
|
Ross K, Sedello AK, Todd GP, Paszkowski-Rogacz M, Bird AW, Ding L, Grinenko T, Behrens K, Hubner N, Mann M, Waskow C, Stocking C, Buchholz F
|
Polycomb group ring finger 1 cooperates with Runx1 in regulating differentiation and self-renewal of hematopoietic cells.
|
Blood 2012 May 3;119(18):4152-61
|
|
Cell Biology
|

|
22411870 |
|
The transcription factor runt-related transcription factor 1 (Runx1) is essential for the establishment of definitive hematopoiesis during embryonic development. In adult blood homeostasis, Runx1 plays a pivotal role in the maturation of lymphocytes and megakaryocytes. Furthermore, Runx1 is required for the regulation of hematopoietic stem and progenitor cells. However, how Runx1 orchestrates self-renewal and lineage choices in combination with other factors is not well understood. In the present study, we describe a genome-scale RNA interference screen to detect genes that cooperate with Runx1 in regulating hematopoietic stem and progenitor cells. We identify the polycomb group protein Pcgf1 as an epigenetic regulator involved in hematopoietic cell differentiation and show that simultaneous depletion of Runx1 and Pcgf1 allows sustained self-renewal while blocking differentiation of lineage marker-negative cells in vitro. We found an up-regulation of HoxA cluster genes on Pcgf1 knock-down that possibly accounts for the increase in self-renewal. Moreover, our data suggest that cells lacking both Runx1 and Pcgf1 are blocked at an early progenitor stage, indicating that a concerted action of the transcription factor Runx1, together with the epigenetic repressor Pcgf1, is necessary for terminal differentiation. The results of the present study uncover a link between transcriptional and epigenetic regulation that is required for hematopoietic differentiation. |
|
Sezgin E, Levental I, Grzybek M, Schwarzmann G, Mueller V, Honigmann A, Belov VN, Eggeling C, Coskun U, Simons K, Schwille P
|
Partitioning, diffusion, and ligand binding of raft lipid analogs in model and cellular plasma membranes.
|
Biochim. Biophys. Acta 2012 Jul;1818(7):1777-84
|
|
Biophysics
|

|
22450237 |
|
Several simplified membrane models featuring coexisting liquid disordered (Ld) and ordered (Lo) lipid phases have been developed to mimic the heterogeneous organization of cellular membranes, and thus, aid our understanding of the nature and functional role of ordered lipid-protein nanodomains, termed "rafts". In spite of their greatly reduced complexity, quantitative characterization of local lipid environments using model membranes is not trivial, and the parallels that can be drawn to cellular membranes are not always evident. Similarly, various fluorescently labeled lipid analogs have been used to study membrane organization and function in vitro, although the biological activity of these probes in relation to their native counterparts often remains uncharacterized. This is particularly true for raft-preferring lipids ("raft lipids", e.g. sphingolipids and sterols), whose domain preference is a strict function of their molecular architecture, and is thus susceptible to disruption by fluorescence labeling. Here, we analyze the phase partitioning of a multitude of fluorescent raft lipid analogs in synthetic Giant Unilamellar Vesicles (GUVs) and cell-derived Giant Plasma Membrane Vesicles (GPMVs). We observe complex partitioning behavior dependent on label size, polarity, charge and position, lipid headgroup, and membrane composition. Several of the raft lipid analogs partitioned into the ordered phase in GPMVs, in contrast to fully synthetic GUVs, in which most raft lipid analogs mis-partitioned to the disordered phase. This behavior correlates with the greatly enhanced order difference between coexisting phases in the synthetic system. In addition, not only partitioning, but also ligand binding of the lipids is perturbed upon labeling: while cholera toxin B binds unlabeled GM1 in the Lo phase, it binds fluorescently labeled GMI exclusively in the Ld phase. Fluorescence correlation spectroscopy (FCS) by stimulated emission depletion (STED) nanoscopy on intact cellular plasma membranes consistently reveals a constant level of confined diffusion for raft lipid analogs that vary greatly in their partitioning behavior, suggesting different physicochemical bases for these phenomena. |
|
Wittig D, Wang X, Walter C, Gerdes HH, Funk RH, Roehlecke C
|
Multi-level communication of human retinal pigment epithelial cells via tunneling nanotubes.
|
PLoS ONE 2012 Mar 22;7(3):e33195
|
|
Medical Biology
|

|
22457742 |
|
Tunneling nanotubes (TNTs) may offer a very specific and effective way of intercellular communication. Here we investigated TNTs in the human retinal pigment epithelial (RPE) cell line ARPE-19. Morphology of TNTs was examined by immunostaining and scanning electron microscopy. To determine the function of TNTs between cells, we studied the TNT-dependent intercellular communication at different levels including electrical and calcium signalling, small molecular diffusion as well as mitochondrial re-localization. Further, intercellular organelles transfer was assayed by FACS analysis. |
|
Gloor Y, Müller-Reichert T, Walch-Solimena C
|
Co-regulation of the arf-activation cycle and phospholipid-signaling during golgi maturation.
|
Commun Integr Biol 2012 Jan 1;5(1):12-5
|
- EMF MPI-CBG
- LMF & EMF CFCI
|
Cell Biology
|

|
22482002 |
Arf-Guanine nucleotide exchange factor; coincidence detection; golgi maturation; phosphatidylinositol 4-kinase |
The Golgi apparatus is the central protein sorting station inside eukaryotic cells. Although many regulators of Golgi trafficking have been identified, little is known about their crosstalk. Both the Arf activation cycle and phosphatidylinositol 4-phosphate metabolism have been recognized as key processes in the regulation of vesicular transport from this organelle. However, the mechanism ensuring the proper co-regulation of these processes has eluded our understanding thus far. We recently identified a physical interaction between the late yeast Golgi Arf activator Sec7p and the PI4-kinase Pik1p, and showed that the two proteins cooperate in the formation of clathrin-coated vesicles. This finding gives the first insight on the coordinated generation of a dual key signal by a small GTPase and a signaling phospholipid at the Golgi. In addition, it opens new perspectives for a better understanding of Golgi maturation through coordinated regulation of highly dynamic lipid and protein composition of this organelle. |
|
Sezgin E, Kaiser HJ, Baumgart T, Schwille P, Simons K, Levental I
|
Elucidating membrane structure and protein behavior using giant plasma membrane vesicles.
|
Nat Protoc 2012 Jun 03;7(6):1042-51
|
|
Biophysics
|

|
22555243 |
|
The observation of phase separation in intact plasma membranes isolated from live cells is a breakthrough for research into eukaryotic membrane lateral heterogeneity, specifically in the context of membrane rafts. These observations are made in giant plasma membrane vesicles (GPMVs), which can be isolated by chemical vesiculants from a variety of cell types and microscopically observed using basic reagents and equipment available in any cell biology laboratory. Microscopic phase separation is detectable by fluorescent labeling, followed by cooling of the membranes below their miscibility phase transition temperature. This protocol describes the methods to prepare and isolate the vesicles, equipment to observe them under temperature-controlled conditions and three examples of fluorescence analysis: (i) fluorescence spectroscopy with an environment-sensitive dye (laurdan); (ii) two-photon microscopy of the same dye; and (iii) quantitative confocal microscopy to determine component partitioning between raft and nonraft phases. GPMV preparation and isolation, including fluorescent labeling and observation, can be accomplished within 4 h. |
|
Aliee M, Röper JC, Landsberg KP, Pentzold C, Widmann TJ, Jülicher F, Dahmann C
|
Physical mechanisms shaping the Drosophila dorsoventral compartment boundary.
|
Curr. Biol. 2012 Jun 5;22(11):967-76
|
|
Developmental Biology
|

|
22560616 |
|
Separating cells with distinct identities and fates by straight and sharp compartment boundaries is important for growth and pattern formation during animal development. The physical mechanisms shaping compartment boundaries, however, are not fully understood. |
|
Mishra M, Rentsch M, Knust E
|
Crumbs regulates polarity and prevents light-induced degeneration of the simple eyes of Drosophila, the ocelli.
|
Eur. J. Cell Biol. 2012 Sep 18;91(9):706-16
|
|
Cell Biology
|

|
22608020 |
|
The evolutionary conserved transmembrane protein Crumbs (Crb) regulates morphogenesis of photoreceptor cells in the compound eye of Drosophila and prevents light-dependent retinal degeneration. Here we examine the role of Crb in the ocelli, the simple eyes of Drosophila. We show that Crb is expressed in ocellar photoreceptor cells, where it defines a stalk membrane apical to the adherens junctions, similar as in photoreceptor cells of the compound eyes. Loss of function of crb disrupts polarity of ocellar photoreceptor cells, and results in mislocalisation of adherens junction proteins. This phenotype is more severe than that observed in mutant photoreceptor cells of the compound eye, and resembles more that of embryonic epithelia lacking crb. Similar as in compound eyes, crb protects ocellar photoreceptors from light induced degeneration, a function that depends on the extracellular portion of the Crb protein. Our data demonstrate that the function of crb in photoreceptor development and homeostasis is conserved in compound eyes and ocelli and underscores the evolutionarily relationship between these visual sense organs of Drosophila. The data will be discussed with respect to the difference in apico-basal organisation of these two cell types. |
|
Zeigerer A, Gilleron J, Bogorad RL, Marsico G, Nonaka H, Seifert S, Epstein-Barash H, Kuchimanchi S, Peng CG, Ruda VM, Del Conte-Zerial P, Hengstler JG, Kalaidzidis Y, Koteliansky V, Zerial M
|
Rab5 is necessary for the biogenesis of the endolysosomal system in vivo.
|
Nature 2012 May 24;485(7399):465-70
|
|
Cell Biology
|

|
22622570 |
|
An outstanding question is how cells control the number and size of membrane organelles. The small GTPase Rab5 has been proposed to be a master regulator of endosome biogenesis. Here, to test this hypothesis, we developed a mathematical model of endosome dependency on Rab5 and validated it by titrating down all three Rab5 isoforms in adult mouse liver using state-of-the-art RNA interference technology. Unexpectedly, the endocytic system was resilient to depletion of Rab5 and collapsed only when Rab5 decreased to a critical level. Loss of Rab5 below this threshold caused a marked reduction in the number of early endosomes, late endosomes and lysosomes, associated with a block of low-density lipoprotein endocytosis. Loss of endosomes caused failure to deliver apical proteins to the bile canaliculi, suggesting a requirement for polarized cargo sorting. Our results demonstrate for the first time, to our knowledge, the role of Rab5 as an endosome organizer in vivo and reveal the resilience mechanisms of the endocytic system. |
|
Sanchez-Fernandez MA, Sbacchi S, Correa-Tapia M, Naumann R, Klemm J, Chambon P, Al-Robaiy S, Blessing M, Hoflack B
|
Transgenic mice for a tamoxifen-induced, conditional expression of the Cre recombinase in osteoclasts.
|
PLoS ONE 2012 May 18;7(5):e37592
|
|
Imaging Technologies Development
|

|
22624050 |
|
Studies on osteoclasts, the bone resorbing cells, have remained limited due to the lack of transgenic mice allowing the conditional knockout of genes in osteoclasts at any time during development or adulthood. |
|
Winter JF, Höpfner S, Korn K, Farnung BO, Bradshaw CR, Marsico G, Volkmer M, Habermann B, Zerial M
|
Caenorhabditis elegans screen reveals role of PAR-5 in RAB-11-recycling endosome positioning and apicobasal cell polarity.
|
Nat. Cell Biol. 2012 Jul 27;14(7):666-76
|
- LMF MPI-CBG
- Screening MPI-CBG
|
Cell Biology
|

|
22634595 |
|
Apically enriched Rab11-positive recycling endosomes (Rab11-REs) are important for establishing and maintaining epithelial polarity. Yet, little is known about the molecules controlling trafficking of Rab11-REs in an epithelium in vivo. Here, we report a genome-wide, image-based RNA interference screen for regulators of Rab11-RE positioning and transport of an apical membrane protein (PEPT-1) in C. elegans intestine. Among the 356 screen hits was the 14-3-3 and partitioning defective protein PAR-5, which we found to be specifically required for Rab11-RE positioning and apicobasal polarity maintenance. Depletion of PAR-5 induced abnormal clustering of Rab11-REs to ectopic sites at the basolateral cortex containing F-actin and other apical domain components. This phenotype required key regulators of F-actin dynamics and polarity, such as Rho GTPases (RHO-1 and the Rac1 orthologue CED-10) and apical PAR proteins. Our data suggest that PAR-5 acts as a regulatory hub for a polarity-maintaining network required for apicobasal asymmetry of F-actin and proper Rab11-RE positioning. |
|
Malinovska L, Kroschwald S, Munder MC, Richter D, Alberti S
|
Molecular chaperones and stress-inducible protein-sorting factors coordinate the spatiotemporal distribution of protein aggregates.
|
Mol. Biol. Cell 2012 Aug 20;23(16):3041-56
|
|
Cell Biology
|
|
22718905 |
|
Acute stress causes a rapid redistribution of protein quality control components and aggregation-prone proteins to diverse subcellular compartments. How these remarkable changes come about is not well understood. Using a phenotypic reporter for a synthetic yeast prion, we identified two protein-sorting factors of the Hook family, termed Btn2 and Cur1, as key regulators of spatial protein quality control in Saccharomyces cerevisiae. Btn2 and Cur1 are undetectable under normal growth conditions but accumulate in stressed cells due to increased gene expression and reduced proteasomal turnover. Newly synthesized Btn2 can associate with the small heat shock protein Hsp42 to promote the sorting of misfolded proteins to a peripheral protein deposition site. Alternatively, Btn2 can bind to the chaperone Sis1 to facilitate the targeting of misfolded proteins to a juxtanuclear compartment. Protein redistribution by Btn2 is accompanied by a gradual depletion of Sis1 from the cytosol, which is mediated by the sorting factor Cur1. On the basis of these findings, we propose a dynamic model that explains the subcellular distribution of misfolded proteins as a function of the cytosolic concentrations of molecular chaperones and protein-sorting factors. Our model suggests that protein aggregation is not a haphazard process but rather an orchestrated cellular response that adjusts the flux of misfolded proteins to the capacities of the protein quality control system. |
|
Cardona A, Saalfeld S, Schindelin J, Arganda-Carreras I, Preibisch S, Longair M, Tomančák P, Hartenstein V, Douglas RJ
|
TrakEM2 software for neural circuit reconstruction.
|
PLoS ONE 2012 Jun 19;7(6):e38011
|
|
Image Processing
|

|
22723842 |
|
A key challenge in neuroscience is the expeditious reconstruction of neuronal circuits. For model systems such as Drosophila and C. elegans, the limiting step is no longer the acquisition of imagery but the extraction of the circuit from images. For this purpose, we designed a software application, TrakEM2, that addresses the systematic reconstruction of neuronal circuits from large electron microscopical and optical image volumes. We address the challenges of image volume composition from individual, deformed images; of the reconstruction of neuronal arbors and annotation of synapses with fast manual and semi-automatic methods; and the management of large collections of both images and annotations. The output is a neural circuit of 3d arbors and synapses, encoded in NeuroML and other formats, ready for analysis. |
|
Sagner A, Merkel M, Aigouy B, Gaebel J, Brankatschk M, Jülicher F, Eaton S
|
Establishment of global patterns of planar polarity during growth of the Drosophila wing epithelium.
|
Curr. Biol. 2012 Jul 24;22(14):1296-301
|
|
Developmental Biology
|

|
22727699 |
|
Epithelial tissues develop planar polarity that is reflected in the global alignment of hairs and cilia with respect to the tissue axes. The planar cell polarity (PCP) proteins form asymmetric and polarized domains across epithelial junctions that are aligned locally between cells and orient these external structures. Although feedback mechanisms can polarize PCP proteins intracellularly and locally align polarity between cells, how global PCP patterns are specified is not understood. It has been proposed that the graded distribution of a biasing factor could guide long-range PCP. However, we recently identified epithelial morphogenesis as a mechanism that can reorganize global PCP patterns; in the Drosophila pupal wing, oriented cell divisions and rearrangements reorient PCP from a margin-oriented pattern to one that points distally. Here, we use quantitative image analysis to study how PCP patterns first emerge in the wing. PCP appears during larval growth and is spatially oriented through the activities of three organizer regions that control disc growth and patterning. Flattening morphogen gradients emanating from these regions does not reduce intracellular polarity but distorts growth and alters specific features of the PCP pattern. Thus, PCP may be guided by morphogenesis rather than morphogen gradients. |
|
Schindelin J, Arganda-Carreras I, Frise E, Kaynig V, Longair M, Pietzsch T, Preibisch S, Rueden C, Saalfeld S, Schmid B, Tinevez JY, White DJ, Hartenstein V, Eliceiri K, Tomančák P, Cardona A
|
Fiji: an open-source platform for biological-image analysis.
|
Nat. Methods 2012 Jul 28;9(7):676-82
|
|
Image Processing
|

|
22743772 |
|
Fiji is a distribution of the popular open-source software ImageJ focused on biological-image analysis. Fiji uses modern software engineering practices to combine powerful software libraries with a broad range of scripting languages to enable rapid prototyping of image-processing algorithms. Fiji facilitates the transformation of new algorithms into ImageJ plugins that can be shared with end users through an integrated update system. We propose Fiji as a platform for productive collaboration between computer science and biology research communities. |
|
Kankaanpää P, Paavolainen L, Tiitta S, Karjalainen M, Päivärinne J, Nieminen J, Marjomäki V, Heino J, White DJ
|
BioImageXD: an open, general-purpose and high-throughput image-processing platform.
|
Nat. Methods 2012 Jul 28;9(7):683-9
|
- IPF MPI-CBG
- LMF CMCB
- LMF MPI-CBG
- LMF & EMF CFCI
|
Image Processing
|

|
22743773 |
|
BioImageXD puts open-source computer science tools for three-dimensional visualization and analysis into the hands of all researchers, through a user-friendly graphical interface tuned to the needs of biologists. BioImageXD has no restrictive licenses or undisclosed algorithms and enables publication of precise, reproducible and modifiable workflows. It allows simple construction of processing pipelines and should enable biologists to perform challenging analyses of complex processes. We demonstrate its performance in a study of integrin clustering in response to selected inhibitors. |
|
Eliceiri KW, Berthold MR, Goldberg IG, Ibáñez L, Manjunath BS, Martone ME, Murphy RF, Peng H, Plant AL, Roysam B, Stuurman N, Stuurmann N, Swedlow JR, Tomancak P, Carpenter AE
|
Biological imaging software tools.
|
Nat. Methods 2012 Jul 28;9(7):697-710
|
|
Image Processing
|

|
22743775 |
|
Few technologies are more widespread in modern biological laboratories than imaging. Recent advances in optical technologies and instrumentation are providing hitherto unimagined capabilities. Almost all these advances have required the development of software to enable the acquisition, management, analysis and visualization of the imaging data. We review each computational step that biologists encounter when dealing with digital images, the inherent challenges and the overall status of available software for bioimage informatics, focusing on open-source options. |
|
Michel M, Kupinski AP, Raabe I, Bökel C
|
Hh signalling is essential for somatic stem cell maintenance in the Drosophila testis niche.
|
Development 2012 Aug 28;139(15):2663-9
|
|
Developmental Biology
|

|
22745310 |
|
In the Drosophila testis, germline stem cells (GSCs) and somatic cyst stem cells (CySCs) are arranged around a group of postmitotic somatic cells, termed the hub, which produce a variety of growth factors contributing to the niche microenvironment that regulates both stem cell pools. Here we show that CySC but not GSC maintenance requires Hedgehog (Hh) signalling in addition to Jak/Stat pathway activation. CySC clones unable to transduce the Hh signal are lost by differentiation, whereas pathway overactivation leads to an increase in proliferation. However, unlike cells ectopically overexpressing Jak/Stat targets, the additional cells generated by excessive Hh signalling remain confined to the testis tip and retain the ability to differentiate. Interestingly, Hh signalling also controls somatic cell populations in the fly ovary and the mammalian testis. Our observations might therefore point towards a higher degree of organisational homology between the somatic components of gonads across the sexes and phyla than previously appreciated. |
|
Foret L, Dawson JE, Villaseñor R, Collinet C, Deutsch A, Brusch L, Zerial M, Kalaidzidis Y, Jülicher F
|
A general theoretical framework to infer endosomal network dynamics from quantitative image analysis.
|
Curr. Biol. 2012 Aug 7;22(15):1381-90
|
|
Imaging Technologies Development
|

|
22748321 |
|
Endocytosis allows the import and distribution of cargo into a series of endosomes with distinct morphological and biochemical characteristics. Our current understanding of endocytic cargo trafficking is based on the kinetics of net cargo transport between endosomal compartments without considering individual endosomes. However, endosomes form a dynamic network of membranes undergoing fusion and fission, thereby continuously exchanging and redistributing cargo. The macroscopic kinetic properties, i.e., the properties of the endosomal network as a whole, result from the collective behaviors of many individual endosomes, a problem so far largely unaddressed. |
|
Rostovskaya M, Fu J, Obst M, Baer I, Weidlich S, Wang H, Smith AJ, Anastassiadis K, Stewart AF
|
Transposon-mediated BAC transgenesis in human ES cells.
|
Nucleic Acids Res. 2012 Oct 30;40(19):e150
|
|
Cell Biology
|

|
22753106 |
|
Transgenesis is a cornerstone of molecular biology. The ability to integrate a specifically engineered piece of DNA into the genome of a living system is fundamental to our efforts to understand life and exploit its implications for medicine, nanotechnology and bioprospecting. However, transgenesis has been hampered by position effects and multi-copy integration problems, which are mainly due to the use of small, plasmid-based transgenes. Large transgenes based on native genomic regions cloned into bacterial artificial chromosomes (BACs) circumvent these problems but are prone to fragmentation. Herein, we report that contrary to widely held notions, large BAC-sized constructs do not prohibit transposition. We also report the first reliable method for BAC transgenesis in human embryonic stem cells (hESCs). The PiggyBac or Sleeping Beauty transposon inverted repeats were integrated into BAC vectors by recombineering, followed by co-lipofection with the corresponding transposase in hESCs to generate robust fluorescent protein reporter lines for OCT4, NANOG, GATA4 and PAX6. BAC transposition delivers several advantages, including increased frequencies of single-copy, full-length integration, which will be useful in all transgenic systems but especially in difficult venues like hESCs. |
|
Bergert M, Chandradoss SD, Desai RA, Paluch E
|
Cell mechanics control rapid transitions between blebs and lamellipodia during migration.
|
Proc. Natl. Acad. Sci. U.S.A. 2012 Sep 4;109(36):14434-9
|
|
Cell Biology
|

|
22786929 |
|
Protrusion formation is an essential step during cell migration. Cells migrating in three-dimensional environments and in vivo can form a wide variety of protrusion types, including actin polymerization-driven lamellipodia, and contractility-driven blebs. The ability to switch between different protrusions has been proposed to facilitate motility in complex environments and to promote cancer dissemination. However, plasticity in protrusion formation has so far mostly been investigated in the context of transitions between amoeboid and mesenchymal migration modes, which involve substantial changes in overall cell morphology. As a result, the minimal requirements of transitions between blebs and lamellipodia, as well as the time scales on which they occur, remain unknown. To address these questions, we investigated protrusion switching during cell migration at the single cell level. Using cells that can be induced to form either blebs or lamellipodia, we systematically assessed the mechanical requirements, as well as the dynamics, of switching between protrusion types. We demonstrate that shifting the balance between actin protrusivity and actomyosin contractility leads to immediate transitions between blebs and lamellipodia in migrating cells. Switching occurred without changes in global cell shape, polarity, or cell adhesion. Furthermore, rapid transitions between blebs and lamellipodia could also be triggered upon changes in substrate adhesion during migration on micropatterned surfaces. Together, our data reveal that the type of protrusion formed by migrating cells can be dynamically controlled independently of overall cell morphology, suggesting that protrusion formation is an autonomous module in the regulatory network that controls the plasticity of cell migration. |
|
Hiller B, Achleitner M, Glage S, Naumann R, Behrendt R, Roers A
|
Mammalian RNase H2 removes ribonucleotides from DNA to maintain genome integrity.
|
J. Exp. Med. 2012 Jul 30;209(8):1419-26
|
|
Cell Biology
|

|
22802351 |
|
Ribonucleases H (RNases H) are endonucleases which cleave the RNA moiety of RNA/DNA hybrids. Their function in mammalian cells is incompletely understood. RNase H2 mutations cause Aicardi-Goutières syndrome, an inflammatory condition clinically overlapping with lupus erythematosus. We show that RNase H2 is essential in mouse embryonic development. RNase H2-deficient cells proliferated slower than control cells and accumulated in G2/M phase due to chronic activation of a DNA damage response associated with an increased frequency of single-strand breaks, increased histone H2AX phosphorylation, and induction of p53 target genes, most prominently the cyclin-dependent kinase inhibitor 1 encoding cell cycle inhibitor p21. RNase H2-deficient cells featured an increased genomic ribonucleotide load, suggesting that unrepaired ribonucleotides trigger the DNA damage response in these cells. Collectively, we show that RNase H2 is essential to remove ribonucleotides from the mammalian genome to prevent DNA damage. |
|
Kizil C, Dudczig S, Kyritsis N, Machate A, Blaesche J, Kroehne V, Brand M
|
The chemokine receptor cxcr5 regulates the regenerative neurogenesis response in the adult zebrafish brain.
|
Neural Dev 2012 Jul 23;7:27
|
- EMF & Histo CMCB
- LMF CMCB
|
Neurobiology
|

|
22824261 |
|
Unlike mammals, zebrafish exhibits extensive neural regeneration after injury in adult stages of its lifetime due to the neurogenic activity of the radial glial cells. However, the genes involved in the regenerative neurogenesis response of the zebrafish brain are largely unknown. Thus, understanding the underlying principles of this regeneration capacity of the zebrafish brain is an interesting research realm that may offer vast clinical ramifications. |
|
Bickle M
|
Systems drug discovery: a quantitative, objective approach for safer drug development.
|
Expert Opin Drug Discov 2012 Sep 25;7(9):757-9
|
|
Imaging Technologies Development
|
|
22827715 |
|
We are currently witnessing a dramatic change in the pharmaceutical industry as many companies are downscaling their efforts to discover new drug candidates and are instead turning toward collaboration with academic partners. This trend has been dubbed open innovation. The reason for this change of policy stems from the realization that, in spite of massive investments in their drug development programs in the past 30 years, the number of new drugs reaching the market has remained stable over the same period. We review past and present drug discovery strategies and present a novel more holistic approach that we term Systems Drug Discovery. This approach aims at quantifying the physiological state of organ slice cultures using high content imaging and metabolomics. The characterization in a quantitative manner of healthy, diseased, and drug-treated tissues will allow defining a multiparametric space, within which tissues are healthy. This in turn will allow an objective assessment of the impact of candidate drugs on cells. This quantitative approach should help guide the development of new drugs reducing failure rates in clinical phase. |
|
Thompson DB, Villaseñor R, Dorr BM, Zerial M, Liu DR
|
Cellular uptake mechanisms and endosomal trafficking of supercharged proteins.
|
Chem. Biol. 2012 Jul 27;19(7):831-43
|
|
Cell Biology
|

|
22840771 |
|
Supercharged proteins (SCPs) can deliver functional macromolecules into the cytoplasm of mammalian cells more potently than unstructured cationic peptides. Thus far, neither the structural features of SCPs that determine their delivery effectiveness nor their intracellular fate postendocytosis, has been studied. Using a large set of supercharged GFP (scGFP) variants, we found that the level of cellular uptake is sigmoidally related to net charge and that scGFPs enter cells through multiple pathways, including clathrin-dependent endocytosis and macropinocytosis. SCPs activate Rho and ERK1/2 and also alter the endocytosis of transferrin and EGF. Finally, we discovered that the intracellular trafficking of endosomes containing scGFPs is altered in a manner that correlates with protein delivery potency. Collectively, our findings establish basic structure-activity relationships of SCPs and implicate the modulation of endosomal trafficking as a determinant of macromolecule delivery efficiency. |
|
Palm W, Sampaio JL, Brankatschk M, Carvalho M, Mahmoud A, Shevchenko A, Eaton S
|
Lipoproteins in Drosophila melanogaster--assembly, function, and influence on tissue lipid composition.
|
PLoS Genet. 2012 Jul 26;8(7):e1002828
|
|
Cell Biology
|

|
22844248 |
|
Interorgan lipid transport occurs via lipoproteins, and altered lipoprotein levels correlate with metabolic disease. However, precisely how lipoproteins affect tissue lipid composition has not been comprehensively analyzed. Here, we identify the major lipoproteins of Drosophila melanogaster and use genetics and mass spectrometry to study their assembly, interorgan trafficking, and influence on tissue lipids. The apoB-family lipoprotein Lipophorin (Lpp) is the major hemolymph lipid carrier. It is produced as a phospholipid-rich particle by the fat body, and its secretion requires Microsomal Triglyceride Transfer Protein (MTP). Lpp acquires sterols and most diacylglycerol (DAG) at the gut via Lipid Transfer Particle (LTP), another fat body-derived apoB-family lipoprotein. The gut, like the fat body, is a lipogenic organ, incorporating both de novo-synthesized and dietary fatty acids into DAG for export. We identify distinct requirements for LTP and Lpp-dependent lipid mobilization in contributing to the neutral and polar lipid composition of the brain and wing imaginal disc. These studies define major routes of interorgan lipid transport in Drosophila and uncover surprising tissue-specific differences in lipoprotein lipid utilization. |
|
Czekaj M, Haas J, Gebhardt M, Müller-Reichert T, Humphries P, Farrar J, Bartsch U, Ader M
|
In vitro expanded stem cells from the developing retina fail to generate photoreceptors but differentiate into myelinating oligodendrocytes.
|
PLoS ONE 2012 Jul 25;7(7):e41798
|
- EMF MPI-CBG
- LMF CMCB
- LMF & EMF CFCI
|
Developmental Biology
|

|
22848612 |
|
Cell transplantation to treat retinal degenerative diseases represents an option for the replacement of lost photoreceptor cells. In vitro expandable cells isolated from the developing mammalian retina have been suggested as a potential source for the generation of high numbers of donor photoreceptors. In this study we used standardized culture conditions based on the presence of the mitogens FGF-2 and EGF to generate high numbers of cells in vitro from the developing mouse retina. These presumptive 'retinal stem cells' ('RSCs') can be propagated as monolayer cultures over multiple passages, express markers of undifferentiated neural cells, and generate neuronal and glial cell types upon withdrawal of mitogens in vitro or following transplantation into the adult mouse retina. The proportion of neuronal differentiation can be significantly increased by stepwise removal of mitogens and inhibition of the notch signaling pathway. However, 'RSCs', by contrast to their primary counterparts in vivo, i.e. retinal progenitor cells, loose the expression of retina-specific progenitor markers like Rax and Chx10 after passaging and fail to differentiate into photoreceptors both in vitro or after intraretinal transplantation. Notably, 'RSCs' can be induced to differentiate into myelinating oligodendrocytes, a cell type not generated by primary retinal progenitor cells. Based on these findings we conclude that 'RSCs' expanded in high concentrations of FGF-2 and EGF loose their retinal identity and acquire features of in vitro expandable neural stem-like cells making them an inappropriate cell source for strategies aimed at replacing photoreceptor cells in the degenerated retina. |
|
Schiller M, Massalski C, Kurth T, Steinebrunner I
|
The Arabidopsis apyrase AtAPY1 is localized in the Golgi instead of the extracellular space.
|
BMC Plant Biol. 2012 Jul 31;12:123
|
- EMF & Histo CMCB
- LMF CMCB
|
Cell Biology
|

|
22849572 |
|
The two highly similar Arabidopsis apyrases AtAPY1 and AtAPY2 were previously shown to be involved in plant growth and development, evidently by regulating extracellular ATP signals. The subcellular localization of AtAPY1 was investigated to corroborate an extracellular function. |
|
Fabig G, Kretschmar S, Weiche S, Eberle D, Ader M, Kurth T
|
Labeling of ultrathin resin sections for correlative light and electron microscopy.
|
Methods Cell Biol. 2012;111:75-93
|
|
Imaging Technologies Development
|

|
22857924 |
|
Correlative microscopy combines the versatility of the light microscope with the excellent spatial resolution of the electron microscope. Here, we describe fast and simple methods for correlative immunofluorescence and immunogold labeling on the very same ultrathin section. The protocols are demonstrated on sections of tissue samples embedded in the methacrylate Lowicryl K4M. Ultrathin sections are mounted on electron microscopy (EM) grids and stained simultaneously with fluorescent and gold markers. For the detection of primary antibodies, we applied either protein A gold or immunoglobulin G (IgG) gold in combination with secondary antibodies coupled to Alexa488 or Alexa555. Alternatively, the correlative marker FluoroNanogold was used, followed by silver enhancement. The samples have to be analyzed first at the light microscope and then in the transmission electron microscope (TEM), because the fluorescence is bleached by the electron beam. Labeled structures selected at the fluorescence microscope can be identified in the TEM and analyzed at high resolution. This way, fluorescent signals can be directly correlated to the corresponding subcellular structures in the area of interest. |
|
Woog I, White S, Büchner M, Srayko M, Müller-Reichert T
|
Correlative light and electron microscopy of intermediate stages of meiotic spindle assembly in the early Caenorhabditis elegans embryo.
|
Methods Cell Biol. 2012;111:223-34
|
- EMF MPI-CBG
- LMF & EMF CFCI
|
Imaging Technologies Development
|

|
22857931 |
|
This chapter is an update of the previously published book chapter "Correlative Light and Electron Microscopy of Early C. elegans Embryos in Mitosis" (Müller-Reichert, Srayko, Hyman, O'Toole, & McDonald, 2007). Here, we have adapted and improved the protocol for the isolated meiotic embryos, which was necessary to meet the specific challenges a researcher faces while investigating the development of very early Caenorhabditis elegans embryos ex-utero. Due to the incompleteness of the eggshell assembly, the meiotic embryo is very fragile and much more susceptible to changes in the environmental conditions than the mitotic ones. To avoid phototoxicity associated with wide-field UV illumination, we stage the meiotic embryos primarily using transmitted visible light. Throughout the staging and high-pressure freezing, we incubate samples in an isotonic embryo buffer. The ex-utero approach allows precise tracking of the developmental events in isolated meiotic embryos, thus facilitating the comparison of structural features between wild-type and mutant or RNAi-treated samples. |
|
Müller-Reichert T, Verkade P
|
Introduction to correlative light and electron microscopy.
|
Methods Cell Biol. 2012;111:xvii-xix
|
|
Imaging Technologies Development
|
|
22857938 |
|
|
|
Kaufmann A, Mickoleit M, Weber M, Huisken J
|
Multilayer mounting enables long-term imaging of zebrafish development in a light sheet microscope.
|
Development 2012 Sep;139(17):3242-7
|
|
Imaging Technologies Development
|

|
22872089 |
|
Light sheet microscopy techniques, such as selective plane illumination microscopy (SPIM), are ideally suited for time-lapse imaging of developmental processes lasting several hours to a few days. The success of this promising technology has mainly been limited by the lack of suitable techniques for mounting fragile samples. Embedding zebrafish embryos in agarose, which is common in conventional confocal microscopy, has resulted in severe growth defects and unreliable results. In this study, we systematically quantified the viability and mobility of zebrafish embryos mounted under more suitable conditions. We found that tubes made of fluorinated ethylene propylene (FEP) filled with low concentrations of agarose or methylcellulose provided an optimal balance between sufficient confinement of the living embryo in a physiological environment over 3 days and optical clarity suitable for fluorescence imaging. We also compared the effect of different concentrations of Tricaine on the development of zebrafish and provide guidelines for its optimal use depending on the application. Our results will make light sheet microscopy techniques applicable to more fields of developmental biology, in particular the multiview long-term imaging of zebrafish embryos and other small organisms. Furthermore, the refinement of sample preparation for in toto and in vivo imaging will promote other emerging optical imaging techniques, such as optical projection tomography (OPT). |
|
Sáenz JP, Sezgin E, Schwille P, Simons K
|
Functional convergence of hopanoids and sterols in membrane ordering.
|
Proc. Natl. Acad. Sci. U.S.A. 2012 Aug 28;109(35):14236-40
|
|
Cell Biology
|

|
22893685 |
|
Liquid-ordered phases are one of two biochemically active membrane states, which until now were thought to be a unique consequence of the interactions between eukaryotic membrane lipids. The formation of a liquid-ordered phase depends crucially on the ordering properties of sterols. However, it is not known whether this capacity exists in organisms that lack sterols, such as bacteria. We show that diplopterol, the simplest bacterial hopanoid, has similar properties and that hopanoids are bacterial "sterol surrogates" with the ability to order saturated lipids and to form a liquid-ordered phase in model membranes. These observations suggest that the evolution of an ordered biochemically active liquid membrane could have evolved before the oxygenation of Earth's surface and the emergence of sterols. |
|
Sarov M, Murray JI, Schanze K, Pozniakovski A, Niu W, Angermann K, Hasse S, Rupprecht M, Vinis E, Tinney M, Preston E, Zinke A, Enst S, Teichgraber T, Janette J, Reis K, Janosch S, Schloissnig S, Ejsmont RK, Slightam C, Xu X, Kim SK, Reinke V, Stewart AF, Snyder M, Waterston RH, Hyman AA
|
A genome-scale resource for in vivo tag-based protein function exploration in C. elegans.
|
Cell 2012 Aug 17;150(4):855-66
|
|
Imaging Technologies Development
|

|
22901814 |
|
Understanding the in vivo dynamics of protein localization and their physical interactions is important for many problems in biology. To enable systematic protein function interrogation in a multicellular context, we built a genome-scale transgenic platform for in vivo expression of fluorescent- and affinity-tagged proteins in Caenorhabditis elegans under endogenous cis regulatory control. The platform combines computer-assisted transgene design, massively parallel DNA engineering, and next-generation sequencing to generate a resource of 14,637 genomic DNA transgenes, which covers 73% of the proteome. The multipurpose tag used allows any protein of interest to be localized in vivo or affinity purified using standard tag-based assays. We illustrate the utility of the resource by systematic chromatin immunopurification and automated 4D imaging, which produced detailed DNA binding and cell/tissue distribution maps for key transcription factor proteins. |
|
Olson SK, Greenan G, Desai A, Müller-Reichert T, Oegema K
|
Hierarchical assembly of the eggshell and permeability barrier in C. elegans.
|
J. Cell Biol. 2012 Aug 20;198(4):731-48
|
- EMF MPI-CBG
- LMF MPI-CBG
- LMF & EMF CFCI
|
Cell Biology
|

|
22908315 |
|
In metazoans, fertilization triggers the assembly of an extracellular coat that constitutes the interface between the embryo and its environment. In nematodes, this coat is the eggshell, which provides mechanical rigidity, prevents polyspermy, and is impermeable to small molecules. Using immunoelectron microscopy, we found that the Caenorhabditis elegans eggshell was composed of an outer vitelline layer, a middle chitin layer, and an inner layer containing chondroitin proteoglycans. The switch between the chitin and proteoglycan layers was achieved by internalization of chitin synthase coincident with exocytosis of proteoglycan-containing cortical granules. Inner layer assembly did not make the zygote impermeable as previously proposed. Instead, correlative light and electron microscopy demonstrated that the permeability barrier was a distinct envelope that formed in a separate step that required fatty acid synthesis, the sugar-modifying enzyme PERM-1, and the acyl chain transfer enzyme DGTR-1. These findings delineate the hierarchy of eggshell assembly and define key molecular mechanisms at each step. |
|
Schröter C, Ares S, Morelli LG, Isakova A, Hens K, Soroldoni D, Gajewski M, Jülicher F, Maerkl SJ, Deplancke B, Oates AC
|
Topology and dynamics of the zebrafish segmentation clock core circuit.
|
PLoS Biol. 2012 Jul 24;10(7):e1001364
|
|
Developmental Biology
|

|
22911291 |
|
During vertebrate embryogenesis, the rhythmic and sequential segmentation of the body axis is regulated by an oscillating genetic network termed the segmentation clock. We describe a new dynamic model for the core pace-making circuit of the zebrafish segmentation clock based on a systematic biochemical investigation of the network's topology and precise measurements of somitogenesis dynamics in novel genetic mutants. We show that the core pace-making circuit consists of two distinct negative feedback loops, one with Her1 homodimers and the other with Her7:Hes6 heterodimers, operating in parallel. To explain the observed single and double mutant phenotypes of her1, her7, and hes6 mutant embryos in our dynamic model, we postulate that the availability and effective stability of the dimers with DNA binding activity is controlled in a "dimer cloud" that contains all possible dimeric combinations between the three factors. This feature of our model predicts that Hes6 protein levels should oscillate despite constant hes6 mRNA production, which we confirm experimentally using novel Hes6 antibodies. The control of the circuit's dynamics by a population of dimers with and without DNA binding activity is a new principle for the segmentation clock and may be relevant to other biological clocks and transcriptional regulatory networks. |
|
Maître JL, Berthoumieux H, Krens SF, Salbreux G, Jülicher F, Paluch E, Heisenberg CP
|
Adhesion functions in cell sorting by mechanically coupling the cortices of adhering cells.
|
Science 2012 Oct 12;338(6104):253-6
|
|
Cell Biology
|

|
22923438 |
|
Differential cell adhesion and cortex tension are thought to drive cell sorting by controlling cell-cell contact formation. Here, we show that cell adhesion and cortex tension have different mechanical functions in controlling progenitor cell-cell contact formation and sorting during zebrafish gastrulation. Cortex tension controls cell-cell contact expansion by modulating interfacial tension at the contact. By contrast, adhesion has little direct function in contact expansion, but instead is needed to mechanically couple the cortices of adhering cells at their contacts, allowing cortex tension to control contact expansion. The coupling function of adhesion is mediated by E-cadherin and limited by the mechanical anchoring of E-cadherin to the cortex. Thus, cell adhesion provides the mechanical scaffold for cell cortex tension to drive cell sorting during gastrulation. |
|
Stirnnagel K, Schupp D, Dupont A, Kudryavtsev V, Reh J, Müllers E, Lamb DC, Lindemann D
|
Differential pH-dependent cellular uptake pathways among foamy viruses elucidated using dual-colored fluorescent particles.
|
Retrovirology 2012 Aug 30;9:71
|
|
Medical Biology
|

|
22935135 |
|
It is thought that foamy viruses (FVs) enter host cells via endocytosis because all FV glycoproteins examined display pH-dependent fusion activities. Only the prototype FV (PFV) glycoprotein has also significant fusion activity at neutral pH, suggesting that its uptake mechanism may deviate from other FVs. To gain new insights into the uptake processes of FV in individual live host cells, we developed fluorescently labeled infectious FVs. |
|
Arumugam S, Chwastek G, Fischer-Friedrich E, Ehrig C, Mönch I, Schwille P
|
Surface topology engineering of membranes for the mechanical investigation of the tubulin homologue FtsZ.
|
Angew. Chem. Int. Ed. Engl. 2012 Nov 19;51(47):11858-62
|
|
Cell Biology
|

|
22936525 |
|
|
|
Seemann E, Kurth T, Entzeroth R
|
Insight into the ultrastructural organisation of sporulated oocysts of Eimeria nieschulzi (Coccidia, Apicomplexa).
|
Parasitol. Res. 2012 Nov 07;111(5):2143-7
|
|
Cell Biology
|

|
22955498 |
|
Sporulated oocysts of Eimeria contain four sporocysts with two sporozoites each and a sporocyst residuum. The developing sporozoites are protected by the sporocyst wall and the robust double-layered oocyst wall. Because of problems with conventional fixatives, high-pressure freezing, followed by freeze substitution was used to achieve optimal ultrastructural preservation of oocysts, sporocysts and sporozoites. After embedding in Epon®, ultrathin sections were examined by electron microscopy to select specific oocyst regions for further investigation by electron tomography (ET). ET allows high-resolution three-dimensional views of subcellular structures within the oocysts and sporocysts. Analysis of several 300 nm sections by ET revealed a network of small tubular structures with a diameter of 70-120 nm inside the sporocysts which is decribed here for the first time. This network connects the residual body in a sporocyst with the endoplasmic reticulum (ER) of the surrounding sporozoites. The network consists of membrane-bound tubules that contain vesicles but no larger organelles like mitochondria. These tubules, named "sporocord", may have a function similar to an "umbilical cord" providing the sporozoites with metabolites for long-term survival. Small vesicular structures inside the ER of the sporozoites, multivesicular structures inside the residual bodies and vesicles in the tubules support this hypothesis. |
|
Diogo R, Tanaka EM
|
Anatomy of the pectoral and forelimb muscles of wildtype and green fluorescent protein-transgenic axolotls and comparison with other tetrapods including humans: a basis for regenerative, evolutionary and developmental studies.
|
J. Anat. 2012 Dec 07;221(6):622-35
|
|
Medical Biology
|

|
22957800 |
|
The axolotl Ambystoma mexicanum is one of the most used model organisms in evolutionary, developmental and regenerative studies, particularly because it can reconstitute a fully functional and complete forelimb/hindlimb. Surprisingly, there is no publication that describes all the pectoral and forelimb muscles of this species or provides a comparative framework between these muscles and those of other model organisms and of modern humans. In the present paper we describe and illustrate all these muscles in A. mexicanum and provide the first report about the myology of adults of a model organism that is based on analyses and dissections of both wildtype animals and transgenic animals that express green fluorescent protein (GFP) in muscle fibers. On the one hand, the inclusion of GFP-transgenic animals allows us to show the muscles as more commonly seen, and thus easier to understand, by current developmental and regenerative biologists. On the other hand, by including wildtype and GFP-transgenic animals and by visualizing these latter animals with and without a simultaneous transmission laser light, we were able to obtain a more complete and clearer understanding of the exact limit of the fleshy and tendinous parts of the muscles and their specific connections with the skeletal elements. This in turn allowed us to settle some controversies in previous anatomical and comparative studies. As most developmental, regenerative and evolutionary biologists are interested in comparing their observations of A. mexicanum with observations in other model organisms, and ultimately in using this information to increase the understanding of human evolution and medicine, we also provide tables showing the homologies between the pectoral and forelimb muscles of axolotls, of model organisms such as mice, frogs and chicken, and of Homo sapiens. An example illustrating the outcomes of using our methodology and of our observations is that they revealed that, contrary to what is often stated in the literature, A. mexicanum has a muscle coracoradialis that has both a well developed proximal fleshy belly and a distal long and thin tendon, supporting the idea that this muscle very likely corresponds to at least part of the amniote biceps brachii. Our observations also: (i) confirmed that the flexores digitorum minimi, interphalangeus digiti 3, pronator quadratus and palmaris profundus 1 are present as distinct muscles in A. mexicanum, supporting the idea that the latter muscle does not correspond to the pronator accessorius of reptiles; (ii) confirmed that the so-called extensor antebrachii radialis is present as a distinct muscle in this species and, importantly, indicated that this muscle corresponds to the supinator of other tetrapods; (iii) showed that, contrary to some other urodeles, including some other Ambystoma species, there is no distinct muscle epitrochleoanconeus in A. mexicanum and; (iv) showed that the ulnar and radial bundles of the abductor et extensor digiti 1 correspond to the abductor pollicis longus and extensor pollicis longus of other tetrapods, respectively. |
|
Pietzsch T, Preibisch S, Tomančák P, Saalfeld S
|
ImgLib2--generic image processing in Java.
|
Bioinformatics 2012 Nov 15;28(22):3009-11
|
|
Image Processing
|

|
22962343 |
|
ImgLib2 is an open-source Java library for n-dimensional data representation and manipulation with focus on image processing. It aims at minimizing code duplication by cleanly separating pixel-algebra, data access and data representation in memory. Algorithms can be implemented for classes of pixel types and generic access patterns by which they become independent of the specific dimensionality, pixel type and data representation. ImgLib2 illustrates that an elegant high-level programming interface can be achieved without sacrificing performance. It provides efficient implementations of common data types, storage layouts and algorithms. It is the data model underlying ImageJ2, the KNIME Image Processing toolbox and an increasing number of Fiji-Plugins. |
|
Rein S, Hagert E, Hanisch U, Lwowski S, Fieguth A, Zwipp H
|
Immunohistochemical analysis of sensory nerve endings in ankle ligaments: a cadaver study.
|
Cells Tissues Organs (Print) 2013 Sep 04;197(1):64-76
|
|
Medical Biology
|

|
22964904 |
|
The aim of this study was to analyze the pattern and types of sensory nerve endings in ankle ligaments using immunohistochemical techniques, in order to gain more insight into functional ankle stability. |
|
Brandt MD, Hübner M, Storch A
|
Brief report: Adult hippocampal precursor cells shorten S-phase and total cell cycle length during neuronal differentiation.
|
Stem Cells 2012 Dec;30(12):2843-7
|
|
Neurobiology
|

|
22987479 |
|
Cell cycle analyses of adult hippocampal neural stem and precursor cells in vivo are challenging, as there is no temporal or local discrimination of different precursor cell populations. All commonly used techniques to determine the cell cycle length of proliferating cells in the adult hippocampus do not allow discrimination between different cell types. Here, we introduce a novel procedure to precisely calculate cell cycle phase lengths of distinct precursor cell populations in vivo and thereby demonstrate a large heterogeneity of cell cycle kinetics within the pool of adult hippocampal precursor cells. Proliferating NeuroD1(+) cells exhibited a significantly faster S-phase progression (T(s) = 10.1 ± 0.6 hours) and shorter total cell cycle length (T(c) = 22.6 ± 0.1 hours) than NeuroD1(-) cells (T(s) = 13.5 ± 0.8 hours, T(c) = 27.0 ± 0.5 hours; p < .05). Dividing glial fibrillary acidic protein (GFAP(+)) cells also showed significantly shorter mean T(s) of 9.7 ± 0.6 hours and T(c) of 22.8 ± 0.5 hours compared to the rest of uncommitted NeuroD1(-) precursors (p < .01). Together, NeuroD1(+) neuronal progenitors and mitotic GFAP(+) radial glia-like cells divide significantly faster than amplifying neural progenitor cells by accelerating their S-phase. S-phase duration seems to determine cell cycle length in the adult hippocampus. |
|
Widlund PO, Podolski M, Reber S, Alper J, Storch M, Hyman AA, Howard J, Drechsel DN
|
One-step purification of assembly-competent tubulin from diverse eukaryotic sources.
|
Mol. Biol. Cell 2012 Nov 19;23(22):4393-401
|
|
Imaging Technologies Development
|

|
22993214 |
|
We have developed a protocol that allows rapid and efficient purification of native, active tubulin from a variety of species and tissue sources by affinity chromatography. The affinity matrix comprises a bacterially expressed, recombinant protein, the TOG1/2 domains from Saccharomyces cerevisiae Stu2, covalently coupled to a Sepharose support. The resin has a high capacity to specifically bind tubulin from clarified crude cell extracts, and, after washing, highly purified tubulin can be eluted under mild conditions. The eluted tubulin is fully functional and can be efficiently assembled into microtubules. The method eliminates the need to use heterologous systems for the study of microtubule-associated proteins and motor proteins, which has been a major issue in microtubule-related research. |
|
Gerisch G, Schroth-Diez B, Müller-Taubenberger A, Ecke M
|
PIP3 waves and PTEN dynamics in the emergence of cell polarity.
|
Biophys. J. 2012 Sep 19;103(6):1170-8
|
|
Biophysics
|

|
22995489 |
|
In a motile eukaryotic cell, front protrusion and tail retraction are superimposed on each other. To single out mechanisms that result in front to tail or in tail to front transition, we separated the two processes in time using cells that oscillate between a full front and a full tail state. State transitions were visualized by total internal reflection fluorescence microscopy using as a front marker PIP3 (phosphatidylinositol [3,4,5] tris-phosphate), and as a tail marker the tumor-suppressor PTEN (phosphatase tensin homolog) that degrades PIP3. Negative fluctuations in the PTEN layer of the membrane gated a local increase in PIP3. In a subset of areas lacking PTEN (PTEN holes), PIP3 was amplified until a propagated wave was initiated. Wave propagation implies that a PIP3 signal is transmitted by a self-sustained process, such that the temporal and spatial profiles of the signal are maintained during passage of the wave across the entire expanse of the cell membrane. Actin clusters were remodeled into a ring along the perimeter of the expanding PIP3 wave. The reverse transition of PIP3 to PTEN was linked to the previous site of wave initiation: where PIP3 decayed first, the entry of PTEN was primed. |
|
Eberle D, Kurth T, Santos-Ferreira T, Wilson J, Corbeil D, Ader M
|
Outer segment formation of transplanted photoreceptor precursor cells.
|
PLoS ONE 2012 Sep 28;7(9):e46305
|
|
Cell Biology
|

|
23029471 |
|
Transplantation of photoreceptor precursor cells (PPCs) into the retina represents a promising treatment for cell replacement in blinding diseases characterized by photoreceptor loss. In preclinical studies, we and others demonstrated that grafted PPCs integrate into the host outer nuclear layer (ONL) and develop into mature photoreceptors. However, a key feature of light detecting photoreceptors, the outer segment (OS) with natively aligned disc membrane staples, has not been studied in detail following transplantation. Therefore, we used as donor cells PPCs isolated from neonatal double transgenic reporter mice in which OSs are selectively labeled by green fluorescent protein while cell bodies are highlighted by red fluorescent protein. PPCs were enriched using CD73-based magnetic associated cell sorting and subsequently transplanted into either adult wild-type or a model of autosomal-dominant retinal degeneration mice. Three weeks post-transplantation, donor photoreceptors were identified based on fluorescent-reporter expression and OS formation was monitored at light and electron microscopy levels. Donor cells that properly integrated into the host wild-type retina developed OSs with the formation of a connecting cilium and well-aligned disc membrane staples similar to the surrounding native cells of the host. Surprisingly, the majority of not-integrated PPCs that remained in the sub-retinal space also generated native-like OSs in wild-type mice and those affected by retinal degeneration. Moreover, they showed an improved photoreceptor maturation and OS formation by comparison to donor cells located on the vitreous side suggesting that environmental cues influence the PPC differentiation and maturation. We conclude that transplanted PPCs, whether integrated or not into the host ONL, are able to generate the cellular structure for effective light detection, a phenomenon observed in wild-type as well as in degenerated retinas. Given that patients suffering from retinitis pigmentosa lose almost all photoreceptors, our findings are of utmost importance for the development of cell-based therapies. |
|
Brambillasca S, Altkrueger A, Colombo SF, Friederich A, Eickelmann P, Mark M, Borgese N, Solimena M
|
CDK5 regulatory subunit-associated protein 1-like 1 (CDKAL1) is a tail-anchored protein in the endoplasmic reticulum (ER) of insulinoma cells.
|
J. Biol. Chem. 2012 Dec 7;287(50):41808-19
|
|
Medical Biology
|

|
23048041 |
|
Genome-wide association studies have led to the identification of numerous susceptibility genes for type 2 diabetes. Among them is Cdkal1, which is associated with reduced ?-cell function and insulin release. Recently, CDKAL1 has been shown to be a methylthiotransferase that modifies tRNA(Lys) to enhance translational fidelity of transcripts, including the one encoding proinsulin. Here, we report that out of several CDKAL1 isoforms deposited in public databases, only isoform 1, which migrates as a 61-kDa protein by SDS-PAGE, is expressed in human islets and pancreatic insulinoma INS-1 and MIN6 cells. We show that CDKAL1 is a novel member of the tail-anchored protein family and exploits the TCR40/Get3-assisted pathway for insertion of its C-terminal transmembrane domain into the endoplasmic reticulum. Using endo-?-N-acetylglucosaminidase H and peptide:N-glycosidase F sensitivity assays on CDKAL1 constructs carrying an N-glycosylation site within the luminal domain, we further established that CDKAL1 is an endoplasmic reticulum-resident protein. Moreover, we observed that silencing CDKAL1 in INS-1 cells reduces the expression of secretory granule proteins prochromogranin A and proICA512/ICA512-TMF, in addition to proinsulin and insulin. This correlated with reduced glucose-stimulated insulin secretion. Taken together, our findings provide new insight into the role of CDKAL1 in insulin-producing cells and help to understand its involvement in the pathogenesis of diabetes. |
|
Behrndt M, Salbreux G, Campinho P, Hauschild R, Oswald F, Roensch J, Grill SW, Heisenberg CP
|
Forces driving epithelial spreading in zebrafish gastrulation.
|
Science 2012 Oct 12;338(6104):257-60
|
|
Biophysics
|

|
23066079 |
|
Contractile actomyosin rings drive various fundamental morphogenetic processes ranging from cytokinesis to wound healing. Actomyosin rings are generally thought to function by circumferential contraction. Here, we show that the spreading of the enveloping cell layer (EVL) over the yolk cell during zebrafish gastrulation is driven by a contractile actomyosin ring. In contrast to previous suggestions, we find that this ring functions not only by circumferential contraction but also by a flow-friction mechanism. This generates a pulling force through resistance against retrograde actomyosin flow. EVL spreading proceeds normally in situations where circumferential contraction is unproductive, indicating that the flow-friction mechanism is sufficient. Thus, actomyosin rings can function in epithelial morphogenesis through a combination of cable-constriction and flow-friction mechanisms. |
|
Okaz E, Argüello-Miranda O, Bogdanova A, Vinod PK, Lipp JJ, Markova Z, Zagoriy I, Novak B, Zachariae W
|
Meiotic prophase requires proteolysis of M phase regulators mediated by the meiosis-specific APC/CAma1.
|
Cell 2012 Oct 26;151(3):603-18
|
|
Cell Biology
|

|
23101628 |
|
Whereas proliferating cells enter M phase shortly after DNA replication, the first M phase of meiosis is preceded by an extended prophase in which homologous chromosomes undergo recombination. Exit from prophase I is controlled by the recombination checkpoint (RC), which, in yeast, represses the meiosis-specific transcription factor Ndt80 required for the expression of B-type cyclins and other M phase regulators. We show that an extended prophase I additionally requires the suppression of latent, mitotic cell-cycle controls by the anaphase-promoting complex (APC/C) and its meiosis-specific activator Ama1, which trigger the degradation of M phase regulators and Ndd1, a subunit of a mitotic transcription factor. ama1? mutants exit from prophase I prematurely and independently of the RC, which results in recombination defects and chromosome missegregation. Thus, control of prophase I by meiotic mechanisms depends on the suppression of the alternative, mitotic mechanisms by a meiosis-specific form of the APC/C. |
|
Heninger AK, Theil A, Wilhelm C, Petzold C, Huebel N, Kretschmer K, Bonifacio E, Monti P
|
IL-7 abrogates suppressive activity of human CD4+CD25+FOXP3+ regulatory T cells and allows expansion of alloreactive and autoreactive T cells.
|
J. Immunol. 2012 Dec 15;189(12):5649-58
|
|
Medical Biology
|

|
23129754 |
|
CD4(+)CD25(+)FOXP3(+) regulatory T cells (Tregs) control the activation and expansion of alloreactive and autoreactive T cell clones. Because uncontrolled activation and expansion of autoreactive T cells occur in an IL-7-rich environment, we explored the possibility that IL-7 may affect the function of Treg. We show that the functional high-affinity IL-7R is expressed on both naive and memory Tregs, and exposure to IL-7 results in STAT-5 phosphorylation. Naive, but not memory, Tregs proliferated greatly and acquired a memory phenotype in the setting of a suppression assay when IL-7 was present. Importantly, the presence of IL-7 abrogated the capacity of Tregs to suppress proliferation of conventional T cells in response to TCR activators, including alloantigens and autoantigens. Removal of IL-7 restored the suppressive function of Tregs. Preblocking of the IL-7R on the Tregs also restored suppressor function, indicating that IL-7 directly affected Treg function. Thus, prolonged periods of homeostatic expansion can temporarily release natural regulatory brakes on T cells, thereby providing an additional mechanism for activating and expanding alloreactive and autoreactive T cells. |
|
Kyritsis N, Kizil C, Zocher S, Kroehne V, Kaslin J, Freudenreich D, Iltzsche A, Brand M
|
Acute inflammation initiates the regenerative response in the adult zebrafish brain.
|
Science 2012 Dec 7;338(6112):1353-6
|
- EMF & Histo CMCB
- LMF CMCB
|
Neurobiology
|

|
23138980 |
|
The zebrafish regenerates its brain after injury and hence is a useful model organism to study the mechanisms enabling regenerative neurogenesis, which is poorly manifested in mammals. Yet the signaling mechanisms initiating such a regenerative response in fish are unknown. Using cerebroventricular microinjection of immunogenic particles and immunosuppression assays, we showed that inflammation is required and sufficient for enhancing the proliferation of neural progenitors and subsequent neurogenesis by activating injury-induced molecular programs that can be observed after traumatic brain injury. We also identified cysteinyl leukotriene signaling as an essential component of inflammation in the regenerative process of the adult zebrafish brain. Thus, our results demonstrate that in zebrafish, in contrast to mammals, inflammation is a positive regulator of neuronal regeneration in the central nervous system. |
|
Vij S, Rink JC, Ho HK, Babu D, Eitel M, Narasimhan V, Tiku V, Westbrook J, Schierwater B, Roy S
|
Evolutionarily ancient association of the FoxJ1 transcription factor with the motile ciliogenic program.
|
PLoS Genet. 2012 Nov 08;8(11):e1003019
|
|
Developmental Biology
|

|
23144623 |
|
It is generally believed that the last eukaryotic common ancestor (LECA) was a unicellular organism with motile cilia. In the vertebrates, the winged-helix transcription factor FoxJ1 functions as the master regulator of motile cilia biogenesis. Despite the antiquity of cilia, their highly conserved structure, and their mechanism of motility, the evolution of the transcriptional program controlling ciliogenesis has remained incompletely understood. In particular, it is presently not known how the generation of motile cilia is programmed outside of the vertebrates, and whether and to what extent the FoxJ1-dependent regulation is conserved. We have performed a survey of numerous eukaryotic genomes and discovered that genes homologous to foxJ1 are restricted only to organisms belonging to the unikont lineage. Using a mis-expression assay, we then obtained evidence of a conserved ability of FoxJ1 proteins from a number of diverse phyletic groups to activate the expression of a host of motile ciliary genes in zebrafish embryos. Conversely, we found that inactivation of a foxJ1 gene in Schmidtea mediterranea, a platyhelminth (flatworm) that utilizes motile cilia for locomotion, led to a profound disruption in the differentiation of motile cilia. Together, all of these findings provide the first evolutionary perspective into the transcriptional control of motile ciliogenesis and allow us to propose a conserved FoxJ1-regulated mechanism for motile cilia biogenesis back to the origin of the metazoans. |
|
Mishra M, Knust E
|
Analysis of the Drosophila compound eye with light and electron microscopy.
|
Methods Mol. Biol. 2013;935:161-82
|
|
Developmental Biology
|

|
23150367 |
|
The Drosophila compound eye is a regular structure, in which about 750 units, called ommatidia, are arranged in a highly regular pattern. Eye development proceeds in a stereotypical fashion, where epithelial cells of the eye imaginal discs are specified, recruited, and differentiated in a sequential order that leads to the highly precise structure of an adult eye. Even small perturbations, for example in signaling pathways that control proliferation, cell death, or differentiation, can impair the regular structure of the eye, which can be easily detected and analyzed. In addition, the Drosophila eye has proven to be an ideal model for studying the genetic control of neurodegeneration, since the eye is not essential for viability. Several human neurodegeneration diseases have been modeled in the fly, leading to a better understanding of the function/misfunction of the respective gene. In many cases, the genes involved and their function are conserved between flies and human. More strikingly, when ectopically expressed in the fly eye some human genes without a Drosophila counterpart can induce neurodegeneration, detectable by aberrant phototaxis, impaired electrophysiology, or defects in eye morphology. These defects are often rather subtle alteration in shape, size, or arrangement of the cells, and can be easily scored at the ultrastructural level. This chapter aims to provide an overview regarding the analysis of the retina by various means. |
|
Gurudev N, Florek M, Corbeil D, Knust E
|
Prominent role of prominin in the retina.
|
Adv. Exp. Med. Biol. 2013;777:55-71
|
|
Cell Biology
|

|
23161075 |
|
Prominin molecules represent a new family of pentaspan membrane glycoproteins expressed throughout the animal kingdom. The name originates from its localization on membrane protrusion, such as microvilli, filopodia, lamellipodia, and microspikes. Following the original description in mouse and human, representative prominin members were found in fish (e.g., Danio rerio), amphibian (Ambystoma mexicanum, Xenopus laevis), worm (Caenorhabditis elegans), and flies (Drosophila melanogaster). Mammalian prominin-1 was identified as a marker of somatic and cancer stem cells and plays an essential role in the visual system, which contributed to increased interest of the medical field in this molecule. Here we summarize recent data from various fields, including Drosophila, which will aid to our understanding of its still elusive function. |
|
Kizil C, Kyritsis N, Dudczig S, Kroehne V, Freudenreich D, Kaslin J, Brand M
|
Regenerative neurogenesis from neural progenitor cells requires injury-induced expression of Gata3.
|
Dev. Cell 2012 Dec 11;23(6):1230-7
|
|
Developmental Biology
|

|
23168169 |
|
The adult zebrafish brain, unlike mammalian counterparts, can regenerate after injury owing to the neurogenic capacity of stem cells with radial glial character. We hypothesized that injury-induced regenerative programs might be turned on after injury in zebrafish brain and enable regenerative neurogenesis. Here we identify one such gene-the transcription factor gata3-which is expressed only after injury in different zebrafish organs. Gata3 is required for reactive proliferation of radial glia cells, subsequent regenerative neurogenesis, and migration of the newborn neurons. We found that these regeneration-specific roles of Gata3 are dependent on the injury because Gata3 overexpression in the unlesioned adult zebrafish brain is not sufficient to induce neurogenesis. Thus, gata3 acts as a specific injury-induced proregenerative factor that is essential for the regenerative capacity in vertebrates. |
|
Pan-Montojo F, Schwarz M, Winkler C, Arnhold M, O'Sullivan GA, Pal A, Said J, Marsico G, Verbavatz JM, Rodrigo-Angulo M, Gille G, Funk RH, Reichmann H
|
Environmental toxins trigger PD-like progression via increased alpha-synuclein release from enteric neurons in mice.
|
Sci Rep 2012 Nov 30;2:898
|
|
Cell Biology
|

|
23205266 |
|
Pathological studies on Parkinson's disease (PD) patients suggest that PD pathology progresses from the enteric nervous system (ENS) and the olfactory bulb into the central nervous system. We have previously shown that environmental toxins acting locally on the ENS mimic this PD-like pathology progression pattern in mice. Here, we show for the first time that the resection of the autonomic nerves stops this progression. Moreover, our results show that an environmental toxin (i.e. rotenone) promotes the release of alpha-synuclein by enteric neurons and that released enteric alpha-synuclein is up-taken by presynaptic sympathetic neurites and retrogradely transported to the soma, where it accumulates. These results strongly suggest that pesticides can initiate the progression of PD pathology and that this progression is based on the transneuronal and retrograde axonal transport of alpha-synuclein. If confirmed in patients, this study would have crucial implications in the strategies used to prevent and treat PD. |
|
Kalinina I, Nandi A, Delivani P, Chacón MR, Klemm AH, Ramunno-Johnson D, Krull A, Lindner B, Pavin N, Tolić-Nørrelykke IM
|
Pivoting of microtubules around the spindle pole accelerates kinetochore capture.
|
Nat. Cell Biol. 2013 Jan 09;15(1):82-7
|
|
Cell Biology
|

|
23222841 |
|
During cell division, spindle microtubules attach to chromosomes through kinetochores, protein complexes on the chromosome. The central question is how microtubules find kinetochores. According to the pioneering idea termed search-and-capture, numerous microtubules grow from a centrosome in all directions and by chance capture kinetochores. The efficiency of search-and-capture can be improved by a bias in microtubule growth towards the kinetochores, by nucleation of microtubules at the kinetochores and at spindle microtubules, by kinetochore movement, or by a combination of these processes. Here we show in fission yeast that kinetochores are captured by microtubules pivoting around the spindle pole, instead of growing towards the kinetochores. This pivoting motion of microtubules is random and independent of ATP-driven motor activity. By introducing a theoretical model, we show that the measured random movement of microtubules and kinetochores is sufficient to explain the process of kinetochore capture. Our theory predicts that the speed of capture depends mainly on how fast microtubules pivot, which was confirmed experimentally by speeding up and slowing down microtubule pivoting. Thus, pivoting motion allows microtubules to explore space laterally, as they search for targets such as kinetochores. |
|
Scolz M, Widlund PO, Piazza S, Bublik DR, Reber S, Peche LY, Ciani Y, Hubner N, Isokane M, Monte M, Ellenberg J, Hyman AA, Schneider C, Bird AW
|
GTSE1 is a microtubule plus-end tracking protein that regulates EB1-dependent cell migration.
|
PLoS ONE 2012 Dec 07;7(12):e51259
|
|
Cell Biology
|

|
23236459 |
|
The regulation of cell migration is a highly complex process that is often compromised when cancer cells become metastatic. The microtubule cytoskeleton is necessary for cell migration, but how microtubules and microtubule-associated proteins regulate multiple pathways promoting cell migration remains unclear. Microtubule plus-end binding proteins (+TIPs) are emerging as important players in many cellular functions, including cell migration. Here we identify a +TIP, GTSE1, that promotes cell migration. GTSE1 accumulates at growing microtubule plus ends through interaction with the EB1+TIP. The EB1-dependent +TIP activity of GTSE1 is required for cell migration, as well as for microtubule-dependent disassembly of focal adhesions. GTSE1 protein levels determine the migratory capacity of both nontransformed and breast cancer cell lines. In breast cancers, increased GTSE1 expression correlates with invasive potential, tumor stage, and time to distant metastasis, suggesting that misregulation of GTSE1 expression could be associated with increased invasive potential. |
|
Pacioni S, Rueger MA, Nisticò G, Bornstein SR, Park DM, McKay RD, Androutsellis-Theotokis A
|
Fast, potent pharmacological expansion of endogenous hes3+/sox2+ cells in the adult mouse and rat hippocampus.
|
PLoS ONE 2012 Dec 10;7(12):e51630
|
|
Medical Biology
|

|
23251599 |
|
The adult hippocampus is involved in learning and memory. As a consequence, it is a brain region of remarkable plasticity. This plasticity exhibits itself both as cellular changes and neurogenesis. For neurogenesis to occur, a population of local stem cells and progenitor cells is maintained in the adult brain and these are able to proliferate and differentiate into neurons which contribute to the hippocampal circuitry. There is much interest in understanding the role of immature cells in the hippocampus, in relation to learning and memory. Methods and mechanisms that increase the numbers of these cells will be valuable in this research field. We show here that single injections of soluble factors into the lateral ventricle of adult rats and mice induces the rapid (within one week) increase in the number of putative stem cells/progenitor cells in the hippocampus. The established progenitor marker Sox2 together with the more recently established marker Hes3, were used to quantify the manipulation of the Sox2/Hes3 double-positive cell population. We report that in both adult rodent species, Sox2+/Hes3+ cell numbers can be increased within one week. The most prominent increase was observed in the hilus of the dentate gyrus. This study presents a fast, pharmacological method to manipulate the numbers of endogenous putative stem cells/progenitor cells. This method may be easily modified to alter the degree of activation (e.g. by the use of osmotic pumps for delivery, or by repeat injections through implanted cannulas), in order to be best adapted to different paradigms of research (neurodegenerative disease, neuroprotection, learning, memory, plasticity, etc). |
|
Nacu E, Glausch M, Le HQ, Damanik FF, Schuez M, Knapp D, Khattak S, Richter T, Tanaka EM
|
Connective tissue cells, but not muscle cells, are involved in establishing the proximo-distal outcome of limb regeneration in the axolotl.
|
Development 2013 Feb 1;140(3):513-8
|
|
Developmental Biology
|

|
23293283 |
|
During salamander limb regeneration, only the structures distal to the amputation plane are regenerated, a property known as the rule of distal transformation. Multiple cell types are involved in limb regeneration; therefore, determining which cell types participate in distal transformation is important for understanding how the proximo-distal outcome of regeneration is achieved. We show that connective tissue-derived blastema cells obey the rule of distal transformation. They also have nuclear MEIS, which can act as an upper arm identity regulator, only upon upper arm amputation. By contrast, myogenic cells do not obey the rule of distal transformation and display nuclear MEIS upon amputation at any proximo-distal level. These results indicate that connective tissue cells, but not myogenic cells, are involved in establishing the proximo-distal outcome of regeneration and are likely to guide muscle patterning. Moreover, we show that, similarly to limb development, muscle patterning in regeneration is influenced by ?-catenin signalling. |
|
Kanczkowski W, Chatzigeorgiou A, Samus M, Tran N, Zacharowski K, Chavakis T, Bornstein SR
|
Characterization of the LPS-induced inflammation of the adrenal gland in mice.
|
Mol. Cell. Endocrinol. 2013 May 22;371(1-2):228-35
|
|
Medical Biology
|

|
23295830 |
|
Systemic administration of endotoxin, which closely mimics the bacteria-induced systemic inflammatory response syndrome (SIRS) can ultimately lead to organ failure. Adrenal gland insufficiency is frequently diagnosed in critically ill patients; however, the underlying mechanisms are still unclear. In the present study, we studied comprehensively the characteristics of adrenal gland dysregulation, including inflammation, leukocyte infiltration and cell death in the adrenal glands in the course of LPS-induced systemic inflammation in mice. LPS enhanced expression of many proinflammatory cytokines, chemokines and adhesion molecules, which resulted in rapid recruitment of leukocytes into the adrenal gland. Furthermore, LPS-mediated inflammation was associated with increased apoptosis of adrenocortical and chromaffin cells. Our results performed in mice, suggest that LPS-induced adrenal gland inflammation and cell death might be mechanisms potentially involved in the adrenal gland dysfunction in patients with sepsis. |
|
Rappa G, Mercapide J, Anzanello F, Le TT, Johlfs MG, Fiscus RR, Wilsch-Bräuninger M, Corbeil D, Lorico A
|
Wnt interaction and extracellular release of prominin-1/CD133 in human malignant melanoma cells.
|
Exp. Cell Res. 2013 Apr 1;319(6):810-9
|
|
Cell Biology
|

|
23318676 |
|
Prominin-1 (CD133) is the first identified gene of a novel class of pentaspan membrane glycoproteins. It is expressed by various epithelial and non-epithelial cells, and notably by stem and cancer stem cells. In non-cancerous cells such as neuro-epithelial and hematopoietic stem cells, prominin-1 is selectively concentrated in plasma membrane protrusions, and released into the extracellular milieu in association with small vesicles. Previously, we demonstrated that prominin-1 contributes to melanoma cells pro-metastatic properties and suggested that it may constitute a molecular target to prevent prominin-1-expressing melanomas from colonizing and growing in lymph nodes and distant organs. Here, we report that three distinct pools of prominin-1 co-exist in cultures of human FEMX-I metastatic melanoma. Morphologically, in addition to the plasma membrane localization, prominin-1 is found within the intracellular compartments, (e.g., Golgi apparatus) and in association with extracellular membrane vesicles. The latter prominin-1-positive structures appeared in three sizes (small, ?40 nm; intermediates ~40-80 nm, and large, >80 nm). Functionally, the down-regulation of prominin-1 in FEMX-I cells resulted in a significant reduction of number of lipid droplets as observed by coherent anti-Stokes Raman scattering image analysis and Oil red O staining, and surprisingly in a decrease in the nuclear localization of beta-catenin, a surrogate marker of Wnt activation. Moreover, the T-cell factor/lymphoid enhancer factor (TCF/LEF) promoter activity was 2 to 4 times higher in parental than in prominin-1-knockdown cells. Collectively, our results point to Wnt signaling and/or release of prominin-1-containing membrane vesicles as mediators of the pro-metastatic activity of prominin-1 in FEMX-I melanoma. |
|
Zhu Y, Carido M, Meinhardt A, Kurth T, Karl MO, Ader M, Tanaka EM
|
Three-dimensional neuroepithelial culture from human embryonic stem cells and its use for quantitative conversion to retinal pigment epithelium.
|
PLoS ONE 2013 Jan 24;8(1):e54552
|
- EMF & Histo CMCB
- LMF CMCB
|
Imaging Technologies Development
|

|
23358448 |
|
A goal in human embryonic stem cell (hESC) research is the faithful differentiation to given cell types such as neural lineages. During embryonic development, a basement membrane surrounds the neural plate that forms a tight, apico-basolaterally polarized epithelium before closing to form a neural tube with a single lumen. Here we show that the three-dimensional epithelial cyst culture of hESCs in Matrigel combined with neural induction results in a quantitative conversion into neuroepithelial cysts containing a single lumen. Cells attain a defined neuroepithelial identity by 5 days. The neuroepithelial cysts naturally generate retinal epithelium, in part due to IGF-1/insulin signaling. We demonstrate the utility of this epithelial culture approach by achieving a quantitative production of retinal pigment epithelial (RPE) cells from hESCs within 30 days. Direct transplantation of this RPE into a rat model of retinal degeneration without any selection or expansion of the cells results in the formation of a donor-derived RPE monolayer that rescues photoreceptor cells. The cyst method for neuroepithelial differentiation of pluripotent stem cells is not only of importance for RPE generation but will also be relevant to the production of other neuronal cell types and for reconstituting complex patterning events from three-dimensional neuroepithelia. |
|
Tüngler V, Staroske W, Kind B, Dobrick M, Kretschmer S, Schmidt F, Krug C, Lorenz M, Chara O, Schwille P, Lee-Kirsch MA
|
Single-stranded nucleic acids promote SAMHD1 complex formation.
|
J. Mol. Med. 2013 Jun 31;91(6):759-70
|
|
Cell Biology
|

|
23371319 |
|
SAM domain and HD domain-containing protein 1 (SAMHD1) is a dGTP-dependent triphosphohydrolase that degrades deoxyribonucleoside triphosphates (dNTPs) thereby limiting the intracellular dNTP pool. Mutations in SAMHD1 cause Aicardi-Goutières syndrome (AGS), an inflammatory encephalopathy that mimics congenital viral infection and that phenotypically overlaps with the autoimmune disease systemic lupus erythematosus. Both disorders are characterized by activation of the antiviral cytokine interferon-? initiated by immune recognition of self nucleic acids. Here we provide first direct evidence that SAMHD1 associates with endogenous nucleic acids in situ. Using fluorescence cross-correlation spectroscopy, we demonstrate that SAMHD1 specifically interacts with ssRNA and ssDNA and establish that nucleic acid-binding and formation of SAMHD1 complexes are mutually dependent. Interaction with nucleic acids and complex formation do not require the SAM domain, but are dependent on the HD domain and the C-terminal region of SAMHD1. We finally demonstrate that mutations associated with AGS exhibit both impaired nucleic acid-binding and complex formation implicating that interaction with nucleic acids is an integral aspect of SAMHD1 function. |
|
Klose S, Flores-Benitez D, Riedel F, Knust E
|
Fosmid-based structure-function analysis reveals functionally distinct domains in the cytoplasmic domain of Drosophila crumbs.
|
G3 (Bethesda) 2013 Feb 01;3(2):153-65
|
|
Cell Biology
|

|
23390593 |
FERM-binding domain; PDZ-binding domain; morphogenesis; polarity |
The evolutionarily conserved transmembrane protein Crumbs is required for epithelial polarity and morphogenesis in the embryo, control of tissue size in imaginal discs and morphogenesis of photoreceptor cells, and prevents light-dependent retinal degeneration. The small cytoplasmic domain contains two highly conserved regions, a FERM (i.e., protein 4.1/ezrin/radixin/moesin)-binding and a PDZ (i.e., postsynaptic density/discs large/ZO-1)-binding domain. Using a fosmid-based transgenomic approach, we analyzed the role of the two domains during invagination of the tracheae and the salivary glands in the Drosophila embryo. We provide data to show that the PDZ-binding domain is essential for the maintenance of cell polarity in both tissues. In contrast, in embryos expressing a Crumbs protein with an exchange of a conserved Tyrosine residue in the FERM-binding domain to an Alanine, both tissues are internalized, despite some initial defects in apical constriction, phospho-Moesin recruitment, and coordinated invagination movements. However, at later stages these embryos fail to undergo dorsal closure, germ band retraction, and head involution. In addition, frequent defects in tracheal fusion were observed. These results suggest stage and/or tissue specific binding partners. We discuss the power of this fosmid-based system for detailed structure-function analyses in comparison to the UAS/Gal4 system. |
|
Sundaramurthy V, Barsacchi R, Samusik N, Marsico G, Gilleron J, Kalaidzidis I, Meyenhofer F, Bickle M, Kalaidzidis Y, Zerial M
|
Integration of chemical and RNAi multiparametric profiles identifies triggers of intracellular mycobacterial killing.
|
Cell Host Microbe 2013 Feb 13;13(2):129-42
|
|
Cell Biology
|

|
23414754 |
|
Pharmacological modulators of host-microbial interactions can in principle be identified using high-content screens. However, a severe limitation of this approach is the lack of insights into the mode of action of compounds selected during the primary screen. To overcome this problem, we developed a combined experimental and computational approach. We designed a quantitative multiparametric image-based assay to measure intracellular mycobacteria in primary human macrophages, screened a chemical library containing FDA-approved drugs, and validated three compounds for intracellular killing of M. tuberculosis. By integrating the multiparametric profiles of the chemicals with those of siRNAs from a genome-wide survey on endocytosis, we predicted and experimentally verified that two compounds modulate autophagy, whereas the third accelerates endosomal progression. Our findings demonstrate the value of integrating small molecules and genetic screens for identifying cellular mechanisms modulated by chemicals. Furthermore, selective pharmacological modulation of host trafficking pathways can be applied to intracellular pathogens beyond mycobacteria. |
|
Maliga Z, Junqueira M, Toyoda Y, Ettinger A, Mora-Bermúdez F, Klemm RW, Vasilj A, Guhr E, Ibarlucea-Benitez I, Poser I, Bonifacio E, Huttner WB, Shevchenko A, Hyman AA
|
A genomic toolkit to investigate kinesin and myosin motor function in cells.
|
Nat. Cell Biol. 2013 Mar 17;15(3):325-34
|
|
Imaging Technologies Development
|

|
23417121 |
|
Coordination of multiple kinesin and myosin motors is required for intracellular transport, cell motility and mitosis. However, comprehensive resources that allow systems analysis of the localization and interplay between motors in living cells do not exist. Here, we generated a library of 243 amino- and carboxy-terminally tagged mouse and human bacterial artificial chromosome transgenes to establish 227 stably transfected HeLa cell lines, 15 mouse embryonic stem cell lines and 1 transgenic mouse line. The cells were characterized by expression and localization analyses and further investigated by affinity-purification mass spectrometry, identifying 191 candidate protein-protein interactions. We illustrate the power of this resource in two ways. First, by characterizing a network of interactions that targets CEP170 to centrosomes, and second, by showing that kinesin light-chain heterodimers bind conventional kinesin in cells. Our work provides a set of validated resources and candidate molecular pathways to investigate motor protein function across cell lineages. |
|
Stöter M, Niederlein A, Barsacchi R, Meyenhofer F, Brandl H, Bickle M
|
CellProfiler and KNIME: open source tools for high content screening.
|
Methods Mol. Biol. 2013;986:105-22
|
|
Image Processing
|

|
23436409 |
|
High content screening (HCS) has established itself in the world of the pharmaceutical industry as an essential tool for drug discovery and drug development. HCS is currently starting to enter the academic world and might become a widely used technology. Given the diversity of problems tackled in academic research, HCS could experience some profound changes in the future, mainly with more imaging modalities and smart microscopes being developed. One of the limitations in the establishment of HCS in academia is flexibility and cost. Flexibility is important to be able to adapt the HCS setup to accommodate the multiple different assays typical of academia. Many cost factors cannot be avoided, but the costs of the software packages necessary to analyze large datasets can be reduced by using Open Source software. We present and discuss the Open Source software CellProfiler for image analysis and KNIME for data analysis and data mining that provide software solutions which increase flexibility and keep costs low. |
|
Rein S, Hanisch U, Zwipp H, Fieguth A, Lwowski S, Hagert E
|
Comparative analysis of inter- and intraligamentous distribution of sensory nerve endings in ankle ligaments: a cadaver study.
|
Foot Ankle Int 2013 Jul 01;34(7):1017-24
|
|
Medical Biology
|

|
23456084 |
ankle; immunohistochemistry; ligaments; proprioception; sensory nerve endings |
The aim of this study was to analyze the inter-, intraligamentous, and side-related patterns of sensory nerve endings in ankle ligaments. |
|
Grotek B, Wehner D, Weidinger G
|
Notch signaling coordinates cellular proliferation with differentiation during zebrafish fin regeneration.
|
Development 2013 Apr 05;140(7):1412-23
|
|
Developmental Biology
|

|
23462472 |
|
Zebrafish can completely regenerate amputated fins via formation of a blastema, a proliferative mass of undifferentiated precursor cells. During regenerative growth, blastema proliferation must be tightly coordinated with cellular differentiation, but little is known about how this is achieved. Here, we show that Notch signaling is essential for maintenance of blastema cells in a proliferative undifferentiated state. We found that the Notch pathway is activated in response to fin amputation in the highly proliferative region of the blastema. Chemical interference with Notch signaling resulted in a complete block of regeneration. Notch signaling was not required for the earliest known cellular processes during blastema formation, i.e. dedifferentiation and migration of osteoblasts, but specifically interfered with proliferation of blastema cells. Interestingly, overactivation of the pathway via misexpression of the intracellular domain of the Notch receptor (NICD) likewise inhibited regenerative outgrowth. In NICD-overexpressing fins, overall blastemal cell proliferation was not enhanced, but expanded into proximal regions where cellular differentiation normally occurs. Similarly, blastemal and epidermal gene expression territories invaded proximal regions upon sustained Notch activation. Concomitantly, NICD overexpression suppressed differentiation of osteoblasts and caused an expansion of the undifferentiated blastema. Together, these data suggest that Notch signaling activity maintains blastemal cells in a proliferative state and thus coordinates proliferation with differentiation during regenerative growth. |
|
Krausz E, Korn K
|
High-content siRNA screening for target identification and validation.
|
Expert Opin Drug Discov 2008 May;3(5):551-64
|
|
Cell Biology
|

|
23484926 |
|
Automated microscopy and image analysis have progressed tremendously over the past 10 years and opened up a new era of high-content screening. In parallel, RNA interference (RNAi) has revolutionized the functional analysis of genes. |
|
Krautz C, Wolk S, Steffen A, Knoch KP, Ceglarek U, Thiery J, Bornstein S, Saeger HD, Solimena M, Kersting S
|
Effects of immunosuppression on alpha and beta cell renewal in transplanted mouse islets.
|
Diabetologia 2013 Jul 27;56(7):1596-604
|
|
Medical Biology
|

|
23532258 |
|
Immunosuppressive drugs used in human islet transplantation interfere with the balance between beta cell renewal and death, and thus may contribute to progressive graft dysfunction. We analysed the influence of immunosuppressants on the proliferation of transplanted alpha and beta cells after syngeneic islet transplantation in streptozotocin-induced diabetic mice. |
|
Götz A, Jessberger R
|
Dendritic cell podosome dynamics does not depend on the F-actin regulator SWAP-70.
|
PLoS ONE 2013 Mar 27;8(3):e60642
|
|
Medical Biology
|

|
23544157 |
|
In addition to classical adhesion structures like filopodia or focal adhesions, dendritic cells similar to macrophages and osteoclasts assemble highly dynamic F-actin structures called podosomes. They are involved in cellular processes such as extracellular matrix degradation, bone resorption by osteoclasts, and trans-cellular diapedesis of lymphocytes. Besides adhesion and migration, podosomes enable dendritic cells to degrade connective tissue by matrix metalloproteinases. SWAP-70 interacts with RhoGTPases and F-actin and regulates migration of dendritic cells. SWAP-70 deficient osteoclasts are impaired in F-actin-ring formation and bone resorption. In the present study, we demonstrate that SWAP-70 is not required for podosome formation and F-actin turnover in dendritic cells. Furthermore, we found that toll-like receptor 4 ligand induced podosome disassembly and podosome-mediated matrix degradation is not affected by SWAP-70 in dendritic cells. Thus, podosome formation and function in dendritic cells is independent of SWAP-70. |
|
Palm W, Swierczynska MM, Kumari V, Ehrhart-Bornstein M, Bornstein SR, Eaton S
|
Secretion and signaling activities of lipoprotein-associated hedgehog and non-sterol-modified hedgehog in flies and mammals.
|
PLoS Biol. 2013 Mar 12;11(3):e1001505
|
|
Developmental Biology
|

|
23554573 |
|
Hedgehog (Hh) proteins control animal development and tissue homeostasis. They activate gene expression by regulating processing, stability, and activation of Gli/Cubitus interruptus (Ci) transcription factors. Hh proteins are secreted and spread through tissue, despite becoming covalently linked to sterol during processing. Multiple mechanisms have been proposed to release Hh proteins in distinct forms; in Drosophila, lipoproteins facilitate long-range Hh mobilization but also contain lipids that repress the pathway. Here, we show that mammalian lipoproteins have conserved roles in Sonic Hedgehog (Shh) release and pathway repression. We demonstrate that lipoprotein-associated forms of Hh and Shh specifically block lipoprotein-mediated pathway inhibition. We also identify a second conserved release form that is not sterol-modified and can be released independently of lipoproteins (Hh-N*/Shh-N*). Lipoprotein-associated Hh/Shh and Hh-N*/Shh-N* have complementary and synergistic functions. In Drosophila wing imaginal discs, lipoprotein-associated Hh increases the amount of full-length Ci, but is insufficient for target gene activation. However, small amounts of non-sterol-modified Hh synergize with lipoprotein-associated Hh to fully activate the pathway and allow target gene expression. The existence of Hh secretion forms with distinct signaling activities suggests a novel mechanism for generating a diversity of Hh responses. |
|
Firmino J, Tinevez JY, Knust E
|
Crumbs affects protein dynamics in anterior regions of the developing Drosophila embryo.
|
PLoS ONE 2013 Mar 21;8(3):e58839
|
|
Developmental Biology
|

|
23555600 |
|
Maintenance of apico-basal polarity is essential for epithelial integrity and requires particular reinforcement during tissue morphogenesis, when cells are reorganised, undergo shape changes and remodel their junctions. It is well established that epithelial integrity during morphogenetic processes depends on the dynamic exchange of adherens junction components, but our knowledge on the dynamics of other proteins and their dynamics during these processes is still limited. The early Drosophila embryo is an ideal system to study membrane dynamics during morphogenesis. Here, morphogenetic activities differ along the anterior-posterior axis, with the extending germband showing a high degree of epithelial remodelling. We developed a Fluorescence Recovery After Photobleaching (FRAP) assay with a higher temporal resolution, which allowed the distinction between a fast and a slow component of recovery of membrane proteins during the germband extension stage. We show for the first time that the recovery kinetics of a general membrane marker, SpiderGFP, differs in the anterior and posterior parts of the embryo, which correlates well with the different morphogenetic activities of the respective embryonic regions. Interestingly, absence of crumbs, a polarity regulator essential for epithelial integrity in the Drosophila embryo, decreases the fast component of SpiderGFP and of the apical marker Stranded at Second-Venus specifically in the anterior region. We suggest that the defects in kinetics observed in crumbs mutant embryos are the first signs of tissue instability in this region, explaining the earlier breakdown of the head epidermis in comparison to that of the trunk, and that diffusion in the plasma membrane is affected by the absence of Crumbs. |
|
Wittig D, Jászai J, Corbeil D, Funk RH
|
Immunohistochemical localization and characterization of putative mesenchymal stem cell markers in the retinal capillary network of rodents.
|
Cells Tissues Organs (Print) 2013 Apr 03;197(5):344-59
|
|
Medical Biology
|

|
23571553 |
|
Perivascular cells of microvascular niches are the prime candidates for being a reservoire of mesenchymal stem cell (MSC)-like cells in many tissues and organs that could serve as a potential source of cells and a target of novel cell-based therapeutic approaches. In the present study, by utilising typical markers of pericytes (neuronal-glial antigen 2, NG2, a chondroitin sulphate proteoglycan) and those of MSCs (CD146 and CD105) and primitive pluripotent cells (sex-determining region Y-box 2, Sox2), the phenotypic traits and the distribution of murine and rat retinal perivascular cells were investigated in situ. Our findings indicate that retinal microvessels of juvenile rodents are highly covered by NG2-positive branching processes of pericytic (perivascular) cells that are less prominent in mature capillary networks of the adult retina. In the adult rodent retinal vascular bed, NG2 labeling is mainly confined to membranes of the cell body resulting in a pearl-chain-like distribution along the vessels. Retinal pericytes, which were identified by their morphology and NG2 expression, simultaneously express CD146. Furthermore, CD146-positive cells located at small arteriole-to-capillary branching points appear more intensely stained than elsewhere. Evidence for a differential expression of the two markers around capillaries that would hint at a clonal heterogeneity among pericytic cells, however, is lacking. In contrast, the expression of CD105 is exclusively restricted to vascular endothelial cells and Sox2 is detected neither in perivascular nor in endothelial cells. In dissociated retinal cultures, however, simultaneous expression of NG2 and CD105 was observed. Collectively, our data indicate that vascular wall resident retinal pericytes share some phenotypic features (i.e. CD146 expression) with archetypal MSCs, which is even more striking in dissociated retinal cultures (i.e. CD105 expression). These findings might have implications for the treatment of retinal pathologies. |
|
Dibenedetto S, Cluet D, Stebe PN, Baumle V, Léault J, Terreux R, Bickle M, Chassey BD, Mikaelian I, Colas P, Spichty M, Zoli M, Rudkin BB
|
Calcineurin A versus NS5A-TP2/HD domain containing 2: a case study of site-directed low-frequency random mutagenesis for dissecting target specificity of peptide aptamers.
|
Mol. Cell Proteomics 2013 Jul 10;12(7):1939-52
|
|
Cell Biology
|

|
23579184 |
|
We previously identified a peptide aptamer (named R5G42) via functional selection for its capacity to slow cell proliferation. A yeast two-hybrid screen of human cDNA libraries, using R5G42 as "bait," allowed the identification of two binding proteins with very different functions: calcineurin A (CnA) (PP2B/PPP3CA), a protein phosphatase well characterized for its role in the immune response, and NS5A-TP2/HD domain containing 2, a much less studied protein induced subsequent to hepatitis C virus non-structural protein 5A expression in HepG2 hepatocellular carcinoma cells, with no known activity. Our objective in the present study was to dissect the dual target specificity of R5G42 in order to have tools with which to better characterize the actions of the peptide aptamers toward their individual targets. This was achieved through the selection of random mutants of the variable loop, derived from R5G42, evaluating their specificity toward CnA and NS5A-TP2 and analyzing their sequence. An interdisciplinary approach involving biomolecular computer simulations with integration of the sequence data and yeast two-hybrid binding phenotypes of these mutants yielded two structurally distinct conformers affording the potential molecular basis of the binding diversity of R5G42. Evaluation of the biological impact of CnA- versus NS5A-TP2-specific peptide aptamers indicated that although both contributed to the anti-proliferative effect of R5G42, CnA-binding was essential to stimulate the nuclear translocation of nuclear factor of activated T cells, indicative of the activation of endogenous CnA. By dissecting the target specificity of R5G42, we have generated novel tools with which to study each target individually. Apta-C8 is capable of directly activating CnA independent of binding to NS5A-TP2 and will be an important tool in studying the role of CnA activation in the regulation of different signaling pathways, whereas Apta-E1 will allow dissection of the function of NS5A-TP2, serving as an example of the usefulness of peptide aptamer technology for investigating signaling pathways. |
|
Liang X, Madrid J, Gärtner R, Verbavatz JM, Schiklenk C, Wilsch-Bräuninger M, Bogdanova A, Stenger F, Voigt A, Howard J
|
A NOMPC-dependent membrane-microtubule connector is a candidate for the gating spring in fly mechanoreceptors.
|
Curr. Biol. 2013 May 6;23(9):755-63
|
|
Cell Biology
|

|
23583554 |
|
Mechanoreceptors contain compliant elements, termed "gating springs," that transfer macroscopic stimuli impinging on the cells into microscopic stimuli that open the mechanosensitive channels. Evidence for gating springs comes from mechanical experiments; they have not been identified molecularly or ultrastructurally. |
|
Audzevich T, Pearce G, Breucha M, Günal G, Jessberger R
|
Control of the STAT6-BCL6 antagonism by SWAP-70 determines IgE production.
|
J. Immunol. 2013 May 15;190(10):4946-55
|
|
Medical Biology
|

|
23589612 |
|
Asthma and allergies are major health concerns in which Ig isotype E plays a pivotal role. Ag-bound IgE drives mast cells and basophils into exocytosis, thereby promoting allergic and potentially anaphylactic reactions. The importance of tightly regulated IgE production is underscored by severe immunological conditions in humans with elevated IgE levels. Cytokines direct IgH class-switching to a particular isotype by initiation of germline transcription (GLT) from isotype-specific intronic (I) promoters. The switch to IgE depends on IL-4, which stimulates GLT of the I? promoter, but is specifically and strongly impaired in Swap-70(-/-) mice. Although early events in IL-4 signal transduction (i.e., activation of the JAK/STAT6 pathway) do not require SWAP-70, SWAP-70 deficiency results in impaired I? GLT. The affinity of STAT6 to chromatin is reduced in absence of SWAP-70. Chromatin immunoprecipitation revealed that SWAP-70 binds to I? and is required for association of STAT6 with I?. BCL6, known to antagonize STAT6 particularly at I?, is increased on I? in absence of SWAP-70. Other promoters bound by BCL6 and STAT6 were found unaffected. We conclude that SWAP-70 controls IgE production through regulation of the antagonistic STAT6 and BCL6 occupancy of I?. The identification of this mechanism opens new avenues to inhibit allergic reactions triggered by IgE. |
|
Kaslin J, Kroehne V, Benato F, Argenton F, Brand M
|
Development and specification of cerebellar stem and progenitor cells in zebrafish: from embryo to adult.
|
Neural Dev 2013 May 04;8:9
|
|
Neurobiology
|

|
23641971 |
|
Teleost fish display widespread post-embryonic neurogenesis originating from many different proliferative niches that are distributed along the brain axis. During the development of the central nervous system (CNS) different cell types are produced in a strict temporal order from increasingly committed progenitors. However, it is not known whether diverse neural stem and progenitor cell types with restricted potential or stem cells with broad potential are maintained in the teleost fish brain. |
|
Zanic M, Widlund PO, Hyman AA, Howard J
|
Synergy between XMAP215 and EB1 increases microtubule growth rates to physiological levels.
|
Nat. Cell Biol. 2013 Jun 12;15(6):688-93
|
|
Cell Biology
|

|
23666085 |
|
In cells, a complex network of proteins regulates the dynamic growth of microtubules that is essential for division and migration. In vitro approaches with purified components have so far been unable to reconstitute fast microtubule growth observed in vivo . Here we show that two well-studied plus-end-binding proteins-end-tracking protein EB1 and microtubule polymerase XMAP215-act together to strongly promote microtubule growth to cellular rates. Unexpectedly, the combined effects of XMAP215 and EB1 are highly synergistic, with acceleration of growth well beyond the product of the individual effects of either protein. The synergistic growth promotion does not rely on any of the canonical EB1 interactions, suggesting an allosteric interaction through the microtubule end. This hypothesis is supported by the finding that taxol and XMAP215, which have non-overlapping binding sites on tubulin, also act synergistically on growth. The increase in growth rates is accompanied by a strong enhancement of microtubule catastrophe by EB1, thereby rendering the fast and dynamic microtubule behaviour typically observed in cells. |
|
Labrador L, Barroso C, Lightfoot J, Müller-Reichert T, Flibotte S, Taylor J, Moerman DG, Villeneuve AM, Martinez-Perez E
|
Chromosome movements promoted by the mitochondrial protein SPD-3 are required for homology search during Caenorhabditis elegans meiosis.
|
PLoS Genet. 2013 May 09;9(5):e1003497
|
- EMF MPI-CBG
- LMF & EMF CFCI
|
Cell Biology
|

|
23671424 |
|
Pairing of homologous chromosomes during early meiosis is essential to prevent the formation of aneuploid gametes. Chromosome pairing includes a step of homology search followed by the stabilization of homolog interactions by the synaptonemal complex (SC). These events coincide with dramatic changes in nuclear organization and rapid chromosome movements that depend on cytoskeletal motors and are mediated by SUN-domain proteins on the nuclear envelope, but how chromosome mobility contributes to the pairing process remains poorly understood. We show that defects in the mitochondria-localizing protein SPD-3 cause a defect in homolog pairing without impairing nuclear reorganization or SC assembly, which results in promiscuous installation of the SC between non-homologous chromosomes. Preventing SC assembly in spd-3 mutants does not improve homolog pairing, demonstrating that SPD-3 is required for homology search at the start of meiosis. Pairing center regions localize to SUN-1 aggregates at meiosis onset in spd-3 mutants; and pairing-promoting proteins, including cytoskeletal motors and polo-like kinase 2, are normally recruited to the nuclear envelope. However, quantitative analysis of SUN-1 aggregate movement in spd-3 mutants demonstrates a clear reduction in mobility, although this defect is not as severe as that seen in sun-1(jf18) mutants, which also show a stronger pairing defect, suggesting a correlation between chromosome-end mobility and the efficiency of pairing. SUN-1 aggregate movement is also impaired following inhibition of mitochondrial respiration or dynein knockdown, suggesting that mitochondrial function is required for motor-driven SUN-1 movement. The reduced chromosome-end mobility of spd-3 mutants impairs coupling of SC assembly to homology recognition and causes a delay in meiotic progression mediated by HORMA-domain protein HTP-1. Our work reveals how chromosome mobility impacts the different early meiotic events that promote homolog pairing and suggests that efficient homology search at the onset of meiosis is largely dependent on motor-driven chromosome movement. |
|
Kappei D, Butter F, Benda C, Scheibe M, Draškovič I, Stevense M, Novo CL, Basquin C, Araki M, Araki K, Krastev DB, Kittler R, Jessberger R, Londoño-Vallejo JA, Mann M, Buchholz F
|
HOT1 is a mammalian direct telomere repeat-binding protein contributing to telomerase recruitment.
|
EMBO J. 2013 Jun 12;32(12):1681-701
|
|
Cell Biology
|

|
23685356 |
|
Telomeres are repetitive DNA structures that, together with the shelterin and the CST complex, protect the ends of chromosomes. Telomere shortening is mitigated in stem and cancer cells through the de novo addition of telomeric repeats by telomerase. Telomere elongation requires the delivery of the telomerase complex to telomeres through a not yet fully understood mechanism. Factors promoting telomerase-telomere interaction are expected to directly bind telomeres and physically interact with the telomerase complex. In search for such a factor we carried out a SILAC-based DNA-protein interaction screen and identified HMBOX1, hereafter referred to as homeobox telomere-binding protein 1 (HOT1). HOT1 directly and specifically binds double-stranded telomere repeats, with the in vivo association correlating with binding to actively processed telomeres. Depletion and overexpression experiments classify HOT1 as a positive regulator of telomere length. Furthermore, immunoprecipitation and cell fractionation analyses show that HOT1 associates with the active telomerase complex and promotes chromatin association of telomerase. Collectively, these findings suggest that HOT1 supports telomerase-dependent telomere elongation. |
|
Poulsen N, Scheffel A, Sheppard VC, Chesley PM, Kröger N
|
Pentalysine clusters mediate silica targeting of silaffins in Thalassiosira pseudonana.
|
J. Biol. Chem. 2013 Jul 12;288(28):20100-9
|
|
Cell Biology
|

|
23720751 |
Biomineralization; Cell Wall; Diatoms; Intracellular Trafficking; Morphogenesis; Post-translational Modification; Protein Motifs; Protein Targeting; Silica; Subcellular Organelles |
The biological formation of inorganic materials (biomineralization) often occurs in specialized intracellular vesicles. Prominent examples are diatoms, a group of single-celled eukaryotic microalgae that produce their SiO2 (silica)-based cell walls within intracellular silica deposition vesicles (SDVs). SDVs contain protein-based organic matrices that control silica formation, resulting in species specifically nanopatterned biosilica, an organic-inorganic composite material. So far no information is available regarding the molecular mechanisms of SDV biogenesis. Here we have investigated by fluorescence microscopy and subcellular membrane fractionation the intracellular transport of silaffin Sil3. Silaffins are a group of phosphoproteins constituting the main components of the organic matrix of diatom biosilica. We demonstrate that the N-terminal signal peptide of Sil3 mediates import into a specific subregion of the endoplasmic reticulum. Additional segments from the mature part of Sil3 are required to reach post-endoplasmic reticulum compartments. Further transport of Sil3 and incorporation into the biosilica (silica targeting) require protein segments that contain a high density of modified lysine residues and phosphoserines. Silica targeting of Sil3 is not dependent on a particular peptide sequence, yet a lysine-rich 12-14-amino acid peptide motif (pentalysine cluster), which is conserved in all silaffins, strongly promotes silica targeting. The results of the present work provide the first insight into the molecular mechanisms for biogenesis of mineral-forming vesicles from an eukaryotic organism. |
|
Kizil C, Iltzsche A, Kaslin J, Brand M
|
Micromanipulation of gene expression in the adult zebrafish brain using cerebroventricular microinjection of morpholino oligonucleotides.
|
J Vis Exp 2013 May 23;(75):e50415
|
|
Neurobiology
|

|
23728426 |
|
Manipulation of gene expression in tissues is required to perform functional studies. In this paper, we demonstrate the cerebroventricular microinjection (CVMI) technique as a means to modulate gene expression in the adult zebrafish brain. By using CVMI, substances can be administered into the cerebroventricular fluid and be thoroughly distributed along the rostrocaudal axis of the brain. We particularly focus on the use of antisense morpholino oligonucleotides, which are potent tools for knocking down gene expression in vivo. In our method, when applied, morpholino molecules are taken up by the cells lining the ventricular surface. These cells include the radial glial cells, which act as neurogenic progenitors. Therefore, knocking down gene expression in the radial glial cells is of utmost importance to analyze the widespread neurogenesis response in zebrafish, and also would provide insight into how vertebrates could sustain adult neurogenesis response. Such an understanding would also help the efforts for clinical applications in human neurodegenerative disorders and central nervous system regeneration. Thus, we present the cerebroventricular microinjection method as a quick and efficient way to alter gene expression and neurogenesis response in the adult zebrafish forebrain. We also provide troubleshooting tips and other useful information on how to carry out the CVMI procedure. |
|
Redemann S, Müller-Reichert T
|
Correlative light and electron microscopy for the analysis of cell division.
|
J Microsc 2013 Aug 04;251(2):109-12
|
|
Imaging Technologies Development
|

|
23734865 |
C. elegans; CLEM; HeLa cells; cytokinesis; electron microscopy; light microscopy; mitosis |
Correlative light and electron microscopy (CLEM) has recently gained increasing attention, because it enables the acquisition of dynamic as well as ultrastructural information about subcellular processes. It is the power of combining the two imaging modalities that gives additional information as compared to using the imaging techniques separately. Here, we briefly summarize two CLEM approaches for the analysis of cells in mitosis and cytokinesis. |
|
Yool AJ, Morelle J, Cnops Y, Verbavatz JM, Campbell EM, Beckett EA, Booker GW, Flynn G, Devuyst O
|
AqF026 is a pharmacologic agonist of the water channel aquaporin-1.
|
J. Am. Soc. Nephrol. 2013 Jun 06;24(7):1045-52
|
|
Cell Biology
|

|
23744886 |
|
Aquaporin-1 (AQP1) facilitates the osmotic transport of water across the capillary endothelium, among other cell types, and thereby has a substantial role in ultrafiltration during peritoneal dialysis. At present, pharmacologic agents that enhance AQP1-mediated water transport, which would be expected to increase the efficiency of peritoneal dialysis, are not available. Here, we describe AqF026, an aquaporin agonist that is a chemical derivative of the arylsulfonamide compound furosemide. In the Xenopus laevis oocyte system, extracellular AqF026 potentiated the channel activity of human AQP1 by >20% but had no effect on channel activity of AQP4. We found that the intracellular binding site for AQP1 involves loop D, a region associated with channel gating. In a mouse model of peritoneal dialysis, AqF026 enhanced the osmotic transport of water across the peritoneal membrane but did not affect the osmotic gradient, the transport of small solutes, or the localization and expression of AQP1 on the plasma membrane. Furthermore, AqF026 did not potentiate water transport in Aqp1-null mice, suggesting that indirect mechanisms involving other channels or transporters were unlikely. Last, in a mouse gastric antrum preparation, AqF026 did not affect the Na-K-Cl cotransporter NKCC1. In summary, AqF026 directly and specifically potentiates AQP1-mediated water transport, suggesting that it deserves additional investigation for applications such as peritoneal dialysis or clinical situations associated with defective water handling. |
|
Duryagina R, Thieme S, Anastassiadis K, Werner C, Schneider S, Wobus M, Brenner S, Bornhäuser M
|
Overexpression of Jagged-1 and its intracellular domain in human mesenchymal stromal cells differentially affect the interaction with hematopoietic stem and progenitor cells.
|
Stem Cells Dev. 2013 Oct 15;22(20):2736-50
|
|
Medical Biology
|

|
23758219 |
|
Mesenchymal stromal cells (MSC) are an important component of the bone marrow microenvironment. Notch ligands expressed by MSC are known to play a regulatory role for hematopoietic stem and progenitor cells (HSPC) and in support of bone marrow homeostasis. While the role of Notch signaling in HSPC, their progeny, and MSC has been relatively well studied, little is known about the Notch-independent regulatory impact of Notch ligands on MSC themselves. In the present study, we used genetically engineered bone marrow-derived human MSC to study the function role of Jagged-1 and the Jagged-1 intracellular domain (JICD) with regard to the interaction with HSPC. We demonstrate that Jagged-1 in human MSC undergoes cleavage to produce an intracellular domain that translocates into the nucleus. JICD but not Jagged-1 overexpression was associated with an increased expression of stromal cell-derived factor-1. Short-term co-culture (7 days) of HSPC with JICD-overexpressing MSC, but not with Jagged-1-overexpressing MSC, led to increased proliferation of CD34(+) progenitors. In contrast, long-term co-culture of HSPC with Jagged-1-overexpressing MSC (up to 6 weeks) led to a significantly better support of cobblestone area-forming cells and long-term culture-initiating cells (LTC-ICs) compared with JICD-overexpressing MSC. Taken together, results of this study indicate that full-length Jagged-1 and JICD have differential effects on MSC and on their interaction with HSPC ex-vivo. JICD-overexpressing MSC induce proliferation of HSPCs in short-term culture at the expense of immature precursors (LTC-ICs), whereas Jagged-1 overexpressing MSC favor LTC-IC formation. |
|
Laugsch M, Seebach J, Schnittler H, Jessberger R
|
Imbalance of SMC1 and SMC3 cohesins causes specific and distinct effects.
|
PLoS ONE 2013 Jun 12;8(6):e65149
|
|
Medical Biology
|

|
23776448 |
|
SMC1 and SMC3 form a high-affinity heterodimer, which provides an open backbone of the cohesin ring, to be closed by a kleisin protein. RNAi mediated knock-down of either one heterodimer partner, SMC1 or SMC3, is expected to cause very similar if not identical phenotypes. However, we observed highly distinct, protein-specific phenotypes. Upon knock-down of human SMC1, much of SMC3 remains stable, accumulates in the cytoplasm and does not associate with other cohesin proteins. Most of the excess nuclear SMC3 is highly mobile and not or only weakly chromosome-associated. In contrast, human SMC3 knock-down rendered SMC1 instable without cytoplasmic accumulation. As observed by differential protein extraction and in FRAP experiments the remaining SMC1 or SMC3 proteins in the respective SMC1 or SMC3 knock-down experiments constituted a cohesin pool, which is associated with chromatin with highest affinity, likely the least expendable. Expression of bovine EGFP-SMC1 or mouse EGFP-SMC3 in human cells under conditions of human SMC1 or SMC3 knock-down rescued the respective phenotypes, but in untreated cells over-expressed exogenous SMC proteins mis-localized. Paucity of either one of the SMC proteins causes RAD21 degradation. These results argue for great caution in interpreting SMC1 and SMC3 RNAi or over-expression experiments. Under challenged conditions these two proteins unexpectedly behave differently, which may have biological consequences for regulation of cohesin-associated functions and for human cohesin pathologies. |
|
Ananthanarayanan V, Schattat M, Vogel SK, Krull A, Pavin N, Tolić-Nørrelykke IM.
|
Dynein motion switches from diffusive to directed upon cortical anchoring.
|
Cell 2013 Jun 20;153(7):1526-36
|
|
Cell Biology
|

|
23791180 |
|
Cytoplasmic dynein is a motor protein that exerts force on microtubules. To generate force for the movement of large organelles, dynein needs to be anchored, with the anchoring sites being typically located at the cell cortex. However, the mechanism by which dyneins target sites where they can generate large collective forces is unknown. Here, we directly observe single dyneins during meiotic nuclear oscillations in fission yeast and identify the steps of the dynein binding process: from the cytoplasm to the microtubule and from the microtubule to cortical anchors. We observed that dyneins on the microtubule move either in a diffusive or directed manner, with the switch from diffusion to directed movement occurring upon binding of dynein to cortical anchors. This dual behavior of dynein on the microtubule, together with the two steps of binding, enables dyneins to self-organize into a spatial pattern needed for them to generate large collective forces. |
|
Gilleron J, Querbes W, Zeigerer A, Borodovsky A, Marsico G, Schubert U, Manygoats K, Seifert S, Andree C, Stöter M, Epstein-Barash H, Zhang L, Koteliansky V, Fitzgerald K, Fava E, Bickle M, Kalaidzidis Y, Akinc A, Maier M, Zerial M
|
Image-based analysis of lipid nanoparticle-mediated siRNA delivery, intracellular trafficking and endosomal escape.
|
Nat. Biotechnol. 2013 Jul 23;31(7):638-46
|
- EMF MPI-CBG
- LMF MPI-CBG
- Screening MPI-CBG
|
Cell Biology
|

|
23792630 |
|
Delivery of short interfering RNAs (siRNAs) remains a key challenge in the development of RNA interference (RNAi) therapeutics. A better understanding of the mechanisms of siRNA cellular uptake, intracellular transport and endosomal release could critically contribute to the improvement of delivery methods. Here we monitored the uptake of lipid nanoparticles (LNPs) loaded with traceable siRNAs in different cell types in vitro and in mouse liver by quantitative fluorescence imaging and electron microscopy. We found that LNPs enter cells by both constitutive and inducible pathways in a cell type-specific manner using clathrin-mediated endocytosis as well as macropinocytosis. By directly detecting colloidal-gold particles conjugated to siRNAs, we estimated that escape of siRNAs from endosomes into the cytosol occurs at low efficiency (1-2%) and only during a limited window of time when the LNPs reside in a specific compartment sharing early and late endosomal characteristics. Our results provide insights into LNP-mediated siRNA delivery that can guide development of the next generation of delivery systems for RNAi therapeutics. |
|
Pabis M, Neufeld N, Steiner MC, Bojic T, Shav-Tal Y, Neugebauer KM
|
The nuclear cap-binding complex interacts with the U4/U6·U5 tri-snRNP and promotes spliceosome assembly in mammalian cells.
|
RNA 2013 Aug 21;19(8):1054-63
|
|
Cell Biology
|

|
23793891 |
cap-binding complex; m7G cap; pre-mRNA splicing; snRNA biogenesis; snRNP |
The nuclear cap-binding complex (CBC) binds to the 7-methyl guanosine cap present on every RNA polymerase II transcript. CBC has been implicated in many aspects of RNA biogenesis; in addition to roles in miRNA biogenesis, nonsense-mediated decay, 3'-end formation, and snRNA export from the nucleus, CBC promotes pre-mRNA splicing. An unresolved question is how CBC participates in splicing. To investigate CBC's role in splicing, we used mass spectrometry to identify proteins that copurify with mammalian CBC. Numerous components of spliceosomal snRNPs were specifically detected. Among these, three U4/U6·U5 snRNP proteins (hBrr2, hPrp4, and hPrp31) copurified with CBC in an RNA-independent fashion, suggesting that a significant fraction of CBC forms a complex with the U4/U6·U5 snRNP and that the activity of CBC might be associated with snRNP recruitment to pre-mRNA. To test this possibility, CBC was depleted from HeLa cells by RNAi. Chromatin immunoprecipitation and live-cell imaging assays revealed decreased cotranscriptional accumulation of U4/U6·U5 snRNPs on active transcription units, consistent with a requirement for CBC in cotranscriptional spliceosome assembly. Surprisingly, recruitment of U1 and U2 snRNPs was also affected, indicating that RNA-mediated interactions between CBC and snRNPs contribute to splicing. On the other hand, CBC depletion did not impair snRNP biogenesis, ruling out the possibility that decreased snRNP recruitment was due to changes in nuclear snRNP concentration. Taken together, the data support a model whereby CBC promotes pre-mRNA splicing through a network of interactions with and among spliceosomal snRNPs during cotranscriptional spliceosome assembly. |
|
Czogalla A, Petrov EP, Kauert DJ, Uzunova V, Zhang Y, Seidel R, Schwille P
|
Switchable domain partitioning and diffusion of DNA origami rods on membranes.
|
Faraday Discuss. 2013;161:31-43; discussion 113-50
|
|
Biophysics
|
|
23805736 |
|
Recently, DNA origami became a powerful tool for custom-shaped functional biomolecules. In this paper, we present the first approach towards assembling amphipathic three-dimensional DNA origami nanostructures and assessing their dynamics on the surface of freestanding phospholipid membranes. Our nanostructures were stiff DNA origami rods comprising six DNA helices. They were functionalized with hydrophobic cholesteryl-ethylene glycol anchors and fluorescently labeled at defined positions. Having these tools in hand, we could demonstrate not only the capability of the amphipathic nanorods to coat membranes of various phospholipid compositions, but also their switchable liquid-ordered/liquid-disordered partitioning on phase separated membranes. The observed translocation of our nanostructures between different domains was controlled by divalent ions. Moreover, selective fluorescent labeling enabled us to distinguish between the translational and rotational diffusion of our six helix bundles on the membranes by fluorescence correlation spectroscopy. The obtained data reveal how DNA origami can be employed as a valuable tool in membrane biophysics. |
|
Viktorinová I, Dahmann C
|
Microtubule polarity predicts direction of egg chamber rotation in Drosophila.
|
Curr. Biol. 2013 Aug 5;23(15):1472-7
|
|
Developmental Biology
|

|
23831293 |
|
Whole-tissue rotations have recently been recognized as a widespread morphogenetic process important for tissue elongation [1-4]. In Drosophila ovaries, elongation of the egg chamber involves a global rotation of the follicle epithelium along the anterior-posterior axis [5]. Individual egg chambers rotate either in a clockwise or counterclockwise direction; however, how the symmetry of egg chambers is broken to allow rotation remains unknown. Here we show that at the basal side of follicle cells, microtubules are preferentially aligned perpendicular to the anterior-posterior axis of the egg chamber. Microtubule depolymerization stalls egg chamber rotation and egg chamber elongation. The preferential alignment of microtubules and egg chamber rotation depend on the atypical cadherin Fat2 and the planar polarized Fat2 localization depends on intact microtubules. Moreover, by tracking microtubule plus-end growth in vivo using EB1::GFP, we find that microtubules are highly polarized in the plane of the follicle epithelium. Polarization of microtubules precedes the onset of egg chamber rotation and predicts the direction of rotation. Our data suggest a feedback amplification mechanism between Fat2 localization and microtubule polarity involved in breaking symmetry and directing egg chamber rotation. |
|
Soukup SF, Pocha SM, Yuan M, Knust E
|
DLin-7 is required in postsynaptic lamina neurons to prevent light-induced photoreceptor degeneration in Drosophila.
|
Curr. Biol. 2013 Jul 22;23(14):1349-54
|
|
Neurobiology
|

|
23850283 |
|
Inherited retinal degeneration in humans is caused by mutations in a wide spectrum of genes that regulate photoreceptor development and homeostasis. Many of these genes are structurally and functionally conserved in Drosophila, making the fly eye an ideal system in which to study the cellular and molecular basis of blindness. DLin-7, the ortholog of vertebrate MALS/Veli, is a core component of the evolutionarily conserved Crumbs complex. Mutations in any core member of the Crb complex lead to retinal degeneration in Drosophila. Strikingly, mutations in the human ortholog, CRB1, result in retinitis pigmentosa 12 (RP12) and Leber congenital amaurosis, two severe retinal dystrophies. Unlike Crumbs, DLin-7 is expressed not only in photoreceptor cells but also in postsynaptic lamina neurons. Here, we show that DLin-7 is required in postsynaptic neurons, but not in photoreceptors such as Crumbs, to prevent light-dependent retinal degeneration. At the photoreceptor synapse, DLin-7 acts as part of a conserved DLin-7/CASK/DlgS97 complex required to control the number of capitate projections and active zones, important specializations in the photoreceptor synapse that are essential for proper neurotransmission. These results are the first to demonstrate that a postsynaptically acting protein prevents light-dependent photoreceptor degeneration and describe a novel, Crumbs-independent mechanism for photoreceptor degeneration. |
|
Liu SY, Selck C, Friedrich B, Lutz R, Vila-Farré M, Dahl A, Brandl H, Lakshmanaperumal N, Henry I, Rink JC
|
Reactivating head regrowth in a regeneration-deficient planarian species.
|
Nature 2013 Aug 1;500(7460):81-4
|
|
Developmental Biology
|

|
23883932 |
|
Species capable of regenerating lost body parts occur throughout the animal kingdom, yet close relatives are often regeneration incompetent. Why in the face of 'survival of the fittest' some animals regenerate but others do not remains a fascinating question. Planarian flatworms are well known and studied for their ability to regenerate from minute tissue pieces, yet species with limited regeneration abilities have been described even amongst planarians. Here we report the characterization of the regeneration defect in the planarian Dendrocoelum lacteum and its successful rescue. Tissue fragments cut from the posterior half of the body of this species are unable to regenerate a head and ultimately die. We find that this defect originates during the early stages of head specification, which require inhibition of canonical Wnt signalling in other planarian species. Notably, RNA interference (RNAi)-mediated knockdown of Dlac-?-catenin-1, the Wnt signal transducer, restored the regeneration of fully functional heads on tail pieces, rescuing D. lacteum's regeneration defect. Our results demonstrate the utility of comparative studies towards the reactivation of regenerative abilities in regeneration-deficient animals. Furthermore, the availability of D. lacteum as a regeneration-impaired planarian model species provides a first step towards elucidating the evolutionary mechanisms that ultimately determine why some animals regenerate and others do not. |
|
Surma MA, Klose C, Peng D, Shales M, Mrejen C, Stefanko A, Braberg H, Gordon DE, Vorkel D, Ejsing CS, Farese R, Simons K, Krogan NJ, Ernst R
|
A lipid E-MAP identifies Ubx2 as a critical regulator of lipid saturation and lipid bilayer stress.
|
Mol. Cell 2013 Aug 22;51(4):519-30
|
|
Cell Biology
|

|
23891562 |
|
Biological membranes are complex, and the mechanisms underlying their homeostasis are incompletely understood. Here, we present a quantitative genetic interaction map (E-MAP) focused on various aspects of lipid biology, including lipid metabolism, sorting, and trafficking. This E-MAP contains ?250,000 negative and positive genetic interaction scores and identifies a molecular crosstalk of protein quality control pathways with lipid bilayer homeostasis. Ubx2p, a component of the endoplasmic-reticulum-associated degradation pathway, surfaces as a key upstream regulator of the essential fatty acid (FA) desaturase Ole1p. Loss of Ubx2p affects the transcriptional control of OLE1, resulting in impaired FA desaturation and a severe shift toward more saturated membrane lipids. Both the induction of the unfolded protein response and aberrant nuclear membrane morphologies observed in cells lacking UBX2 are suppressed by the supplementation of unsaturated FAs. Our results point toward the existence of dedicated bilayer stress responses for membrane homeostasis. |
|
Schumacher M, Lode A, Helth A, Gelinsky M
|
A novel strontium(II)-modified calcium phosphate bone cement stimulates human-bone-marrow-derived mesenchymal stem cell proliferation and osteogenic differentiation in vitro.
|
Acta Biomater 2013 Dec 31;9(12):9547-57
|
|
Medical Biology
|

|
23917042 |
Calcium phosphate bone cement; Cell biological evaluation; Human mesenchymal stem cells; Osteoblasts; Strontium |
In the present study, the in vitro effects of novel strontium-modified calcium phosphate bone cements (SrCPCs), prepared using two different approaches on human-bone-marrow-derived mesenchymal stem cells (hMSCs), were evaluated. Strontium ions, known to stimulate bone formation and therefore already used in systemic osteoporosis therapy, were incorporated into a hydroxyapatite-forming calcium phosphate bone cement via two simple approaches: incorporation of strontium carbonate crystals and substitution of Ca(2+) by Sr(2+) ions during cement setting. All modified cements released 0.03-0.07 mM Sr(2+) under in vitro conditions, concentrations that were shown not to impair the proliferation or osteogenic differentiation of hMSCs. Furthermore, strontium modification led to a reduced medium acidification and Ca(2+) depletion in comparison to the standard calcium phosphate cement. In indirect and direct cell culture experiments with the novel SrCPCs significantly enhanced cell proliferation and differentiation were observed. In conclusion, the SrCPCs described here could be beneficial for the local treatment of defects, especially in the osteoporotic bone. |
|
Chacón-Martínez CA, Kiessling N, Winterhoff M, Faix J, Müller-Reichert T, Jessberger R
|
The switch-associated protein 70 (SWAP-70) bundles actin filaments and contributes to the regulation of F-actin dynamics.
|
J. Biol. Chem. 2013 Oct 4;288(40):28687-703
|
- EMF MPI-CBG
- LMF MPI-CBG
- LMF & EMF CFCI
|
Medical Biology
|

|
23921380 |
Actin; Cell Biology; Cofilin; Cytoskeleton; F-actin Bundling; Mast Cell; SWAP-70 |
Coordinated assembly and disassembly of actin into filaments and higher order structures such as stress fibers and lamellipodia are fundamental for cell migration and adhesion. However, the precise spatiotemporal regulation of F-actin structures is not completely understood. SWAP-70, a phosphatidylinositol 3,4,5-trisphosphate-interacting, F-actin-binding protein, participates in actin rearrangements through yet unknown mechanisms. Here, we show that SWAP-70 is an F-actin-bundling protein that oligomerizes through a Gln/Glu-rich stretch within a coiled-coil region. SWAP-70 bundles filaments in parallel and anti-parallel fashion through its C-terminal F-actin binding domain and delays dilution-induced F-actin depolymerization. We further demonstrate that SWAP-70 co-localizes and directly interacts with cofilin, an F-actin severing and depolymerization factor, and contributes to the regulation of cofilin activity in vivo. In line with these activities, upon stem cell factor stimulation, murine bone marrow-derived mast cells lacking SWAP-70 display aberrant regulation of F-actin and actin free barbed ends dynamics. Moreover, proper stem cell factor-dependent cofilin activation via dephosphorylation and subcellular redistribution into a detergent-resistant cytoskeletal compartment also require SWAP-70. Together, these findings reveal an important role of SWAP-70 in the dynamic spatiotemporal regulation of F-actin networks. |
|
Ivanova A, Kalaidzidis Y, Dirkx R, Sarov M, Gerlach M, Schroth-Diez B, Müller A, Liu Y, Andree C, Mulligan B, Münster C, Kurth T, Bickle M, Speier S, Anastassiadis K, Solimena M
|
Age-dependent labeling and imaging of insulin secretory granules.
|
Diabetes 2013 Nov 08;62(11):3687-96
|
- EMF & Histo CMCB
- IPF MPI-CBG
- LMF MPI-CBG
- Screening MPI-CBG
|
Cell Biology
|

|
23929935 |
|
Insulin is stored within the secretory granules of pancreatic ?-cells, and impairment of its release is the hallmark of type 2 diabetes. Preferential exocytosis of newly synthesized insulin suggests that granule aging is a key factor influencing insulin secretion. Here, we illustrate a technology that enables the study of granule aging in insulinoma cells and ?-cells of knock-in mice through the conditional and unequivocal labeling of insulin fused to the SNAP tag. This approach, which overcomes the limits encountered with previous strategies based on radiolabeling or fluorescence timer proteins, allowed us to formally demonstrate the preferential release of newly synthesized insulin and reveal that the motility of cortical granules significantly changes over time. Exploitation of this approach may enable the identification of molecular signatures associated with granule aging and unravel possible alterations of granule turnover in diabetic ?-cells. Furthermore, the method is of general interest for the study of membrane traffic and aging. |
|
Clark AG, Dierkes K, Paluch EK
|
Monitoring actin cortex thickness in live cells.
|
Biophys. J. 2013 Aug 6;105(3):570-80
|
|
Biophysics
|

|
23931305 |
|
Animal cell shape is controlled primarily by the actomyosin cortex, a thin cytoskeletal network that lies directly beneath the plasma membrane. The cortex regulates cell morphology by controlling cellular mechanical properties, which are determined by network structure and geometry. In particular, cortex thickness is expected to influence cell mechanics. However, cortex thickness is near the resolution limit of the light microscope, making studies relating cortex thickness and cell shape challenging. To overcome this, we developed an assay to measure cortex thickness in live cells, combining confocal imaging and subresolution image analysis. We labeled the actin cortex and plasma membrane with chromatically different fluorophores and measured the distance between the resulting intensity peaks. Using a theoretical description of cortex geometry and microscopic imaging, we extracted an average cortex thickness of ?190 nm in mitotic HeLa cells and tested the validity of our assay using cell images generated in silico. We found that thickness increased after experimental treatments preventing F-actin disassembly. Finally, we monitored physiological changes in cortex thickness in real-time during actin cortex regrowth in cellular blebs. Our investigation paves the way to understanding how molecular processes modulate cortex structure, which in turn drives cell morphogenesis. |
|
Kupinski AP, Raabe I, Michel M, Ail D, Brusch L, Weidemann T, Bökel C
|
Phosphorylation of the Smo tail is controlled by membrane localisation and is dispensable for clustering.
|
J. Cell. Sci. 2013 Oct 15;126(Pt 20):4684-97
|
|
Cell Biology
|

|
23943866 |
Activation state reporter; Fluorescence cross-correlation spectroscopy; Hedgehog; Signal transduction; Smoothened |
The Hedgehog (Hh) signalling cascade is highly conserved and involved in development and disease throughout evolution. Nevertheless, in comparison with other pathways, our mechanistic understanding of Hh signal transduction is remarkably incomplete. In the absence of ligand, the Hh receptor Patched (Ptc) represses the key signal transducer Smoothened (Smo) through an unknown mechanism. Hh binding to Ptc alleviates this repression, causing Smo redistribution to the plasma membrane, phosphorylation and opening of the Smo cytoplasmic tail, and Smo oligomerisation. However, the order and interdependence of these events is as yet poorly understood. We have mathematically modelled and simulated Smo activation for two alternative modes of pathway activation, with Ptc primarily affecting either Smo localisation or phosphorylation. Visualising Smo activation through a novel, fluorescence-based reporter allowed us to test these competing models. Here, we show that Smo localisation to the plasma membrane is sufficient for phosphorylation of the cytoplasmic tail in the presence of Ptc. Using fluorescence cross-correlation spectroscopy (FCCS), we also demonstrate that inactivation of Ptc by Hh induces Smo clustering irrespective of Smo phosphorylation. Our observations therefore support a model of Hh signal transduction whereby Smo subcellular localisation and not phosphorylation is the primary target of Ptc function. |
|
Reber SB, Baumgart J, Widlund PO, Pozniakovsky A, Howard J, Hyman AA, Jülicher F
|
XMAP215 activity sets spindle length by controlling the total mass of spindle microtubules.
|
Nat. Cell Biol. 2013 Sep 25;15(9):1116-22
|
|
Cell Biology
|

|
23974040 |
|
Metaphase spindles are microtubule-based structures that use a multitude of proteins to modulate their morphology and function. Today, we understand many details of microtubule assembly, the role of microtubule-associated proteins, and the action of molecular motors. Ultimately, the challenge remains to understand how the collective behaviour of these nanometre-scale processes gives rise to a properly sized spindle on the micrometre scale. By systematically engineering the enzymatic activity of XMAP215, a processive microtubule polymerase, we show that Xenopus laevis spindle length increases linearly with microtubule growth velocity, whereas other parameters of spindle organization, such as microtubule density, lifetime and spindle shape, remain constant. We further show that mass balance can be used to link the global property of spindle size to individual microtubule dynamic parameters. We propose that spindle length is set by a balance of non-uniform nucleation and global microtubule disassembly in a liquid-crystal-like arrangement of microtubules. |
|
Özhan G, Sezgin E, Wehner D, Pfister AS, Kühl SJ, Kagermeier-Schenk B, Kühl M, Schwille P, Weidinger G
|
Lypd6 enhances Wnt/β-catenin signaling by promoting Lrp6 phosphorylation in raft plasma membrane domains.
|
Dev. Cell 2013 Aug 26;26(4):331-45
|
|
Cell Biology
|

|
23987510 |
|
Wnt/β-catenin signaling plays critical roles during embryogenesis, tissue homeostasis, and regeneration. How Wnt-receptor complex activity is regulated is not yet fully understood. Here, we identify the Ly6 family protein LY6/PLAUR domain-containing 6 (Lypd6) as a positive feedback regulator of Wnt/β-catenin signaling. lypd6 enhances Wnt signaling in zebrafish and Xenopus embryos and in mammalian cells, and it is required for wnt8-mediated patterning of the mesoderm and neuroectoderm during zebrafish gastrulation. Lypd6 is GPI anchored to the plasma membrane and physically interacts with the Wnt receptor Frizzled8 and the coreceptor Lrp6. Biophysical and biochemical evidence indicates that Lypd6 preferentially localizes to raft membrane domains, where Lrp6 is phosphorylated upon Wnt stimulation. lypd6 knockdown or mislocalization of the Lypd6 protein to nonraft membrane domains shifts Lrp6 phosphorylation to these domains and inhibits Wnt signaling. Thus, Lypd6 appears to control Lrp6 activation specifically in membrane rafts, which is essential for downstream signaling. |
|
Zanin E, Desai A, Poser I, Toyoda Y, Andree C, Moebius C, Bickle M, Conradt B, Piekny A, Oegema K
|
A conserved RhoGAP limits M phase contractility and coordinates with microtubule asters to confine RhoA during cytokinesis.
|
Dev. Cell 2013 Sep 16;26(5):496-510
|
|
Cell Biology
|

|
24012485 |
|
During animal cell cytokinesis, the spindle directs contractile ring assembly by activating RhoA in a narrow equatorial zone. Rapid GTPase activating protein (GAP)-mediated inactivation (RhoA flux) is proposed to limit RhoA zone dimensions. Testing the significance of RhoA flux has been hampered by the fact that the GAP targeting RhoA is not known. Here, we identify M phase GAP (MP-GAP) as the primary GAP targeting RhoA during mitosis and cytokinesis. MP-GAP inhibition caused excessive RhoA activation in M phase, leading to the uncontrolled formation of large cortical protrusions and late cytokinesis failure. RhoA zone width was broadened by attenuation of the centrosomal asters but was not affected by MP-GAP inhibition alone. Simultaneous aster attenuation and MP-GAP inhibition led to RhoA accumulation around the entire cell periphery. These results identify the major GAP restraining RhoA during cell division and delineate the relative contributions of RhoA flux and centrosomal asters in controlling RhoA zone dimensions. |
|
Coelho M, Dereli A, Haese A, Kühn S, Malinovska L, DeSantis ME, Shorter J, Alberti S, Gross T, Tolić-Nørrelykke IM.
|
Fission yeast does not age under favorable conditions, but does so after stress.
|
Curr. Biol. 2013 Oct 7;23(19):1844-52
|
|
Cell Biology
|

|
24035542 |
|
Many unicellular organisms age: as time passes, they divide more slowly and ultimately die. In budding yeast, asymmetric segregation of cellular damage results in aging mother cells and rejuvenated daughters. We hypothesize that the organisms in which this asymmetry is lacking, or can be modulated, may not undergo aging. |
|
de Oliveira-Carlos V, Ganz J, Hans S, Kaslin J, Brand M
|
Notch receptor expression in neurogenic regions of the adult zebrafish brain.
|
PLoS ONE 2013 Sep 09;8(9):e73384
|
- EMF & Histo CMCB
- LMF CMCB
|
Neurobiology
|

|
24039926 |
|
The adult zebrash brain has a remarkable constitutive neurogenic capacity. The regulation and maintenance of its adult neurogenic niches are poorly understood. In mammals, Notch signaling is involved in stem cell maintenance both in embryonic and adult CNS. To better understand how Notch signaling is involved in stem cell maintenance during adult neurogenesis in zebrafish we analysed Notch receptor expression in five neurogenic zones of the adult zebrafish brain. Combining proliferation and glial markers we identified several subsets of Notch receptor expressing cells. We found that 90 [Formula: see text] of proliferating radial glia express notch1a, notch1b and notch3. In contrast, the proliferating non-glial populations of the dorsal telencephalon and hypothalamus rarely express notch3 and about half express notch1a/1b. In the non-proliferating radial glia notch3 is the predominant receptor throughout the brain. In the ventral telencephalon and in the mitotic area of the optic tectum, where cells have neuroepithelial properties, notch1a/1b/3 are expressed in most proliferating cells. However, in the cerebellar niche, although progenitors also have neuroepithelial properties, only notch1a/1b are expressed in a high number of PCNA [Formula: see text] cells. In this region notch3 expression is mostly in Bergmann glia and at low levels in few PCNA [Formula: see text] cells. Additionally, we found that in the proliferation zone of the ventral telencephalon, Notch receptors display an apical high to basal low gradient of expression. Notch receptors are also expressed in subpopulations of oligodendrocytes, neurons and endothelial cells. We suggest that the partial regional heterogeneity observed for Notch expression in progenitor cells might be related to the cellular diversity present in each of these neurogenic niches. |
|
Klotzsche-von Ameln A, Prade I, Grosser M, Kettelhake A, Rezaei M, Chavakis T, Flamme I, Wielockx B, Breier G
|
PHD4 stimulates tumor angiogenesis in osteosarcoma cells via TGF-α.
|
Mol. Cancer Res. 2013 Nov 18;11(11):1337-48
|
|
Medical Biology
|

|
24048703 |
|
Solid tumor growth is intimately associated with angiogenesis, a process that is efficiently triggered by hypoxia. Therefore, oxygen-sensitive signaling pathways are thought to play a critical role in tumor angiogenesis and progression. Here, the function of prolyl hydroxylase-4 (PHD4), a relative of the prolyl hydroxylase domain proteins 1-3 that promote the degradation of hypoxia-inducible factors (HIF), was interrogated. To test the hypothesis that PHD4 might inhibit tumor angiogenesis, it was overexpressed in osteosarcoma cells, and unexpectedly, this manipulation led to increased tumor blood vessel density. However, the newly formed blood vessels were smaller than normal and appeared to be partially nonfunctional, as indicated by poor vessel perfusion. PHD4 overexpression in tumor cells stimulated the expression of TGF-α, which was necessary and sufficient to promote angiogenic sprouting of endothelial cells. On the other hand, PHD4 overexpression reduced HIF-2α protein levels, which in turn inhibited in vivo tumor growth. Combined, elevated PHD4 levels deregulate angiogenesis via increased TGF-α expression in vitro and in vivo. These data support the hypothesis that tumor growth can be uncoupled from vessel density and that the individual PHD family members exert distinct functions in tumors.
IMPLICATIONS:
PHD4 influences tumor growth and vascularization through discrete mechanisms and molecular pathways that likely have therapeutic potential. |
|
Boucherie S, Decaens C, Verbavatz JM, Grosse B, Erard M, Merola F, Cassio D, Combettes L
|
Cadmium disorganises the scaffolding of gap and tight junction proteins in the hepatic cell line WIF B9.
|
Biol. Cell 2013 Dec 11;105(12):561-75
|
|
Cell Biology
|

|
24117459 |
cadmium; claudins and connexins; gap and tight junctions; hepatocytes |
Hepatocytes, which perform the main functions of the liver, are particularly vulnerable to toxic agents such as cadmium, an environmental pollutant. To identify the molecular targets for cadmium in hepatocytes, we have studied the effects of CdCl2 on the hybrid cell line WIF-B9 that exhibits stable structural and functional hepatocytic polarity. |
|
Martos A, Petrasek Z, Schwille P
|
Propagation of MinCDE waves on free-standing membranes.
|
Environ. Microbiol. 2013 Dec 31;15(12):3319-26
|
|
Biophysics
|

|
24118679 |
|
As a spatial modulator of cytokinesis in Escherichia coli, the Min system cooperates with the nucleoid occlusion mechanism to target the divisome assembly towards mid-cell. Based on a reaction-diffusion mechanism powered by ATP (adenosine triphosphate) hydrolysis, the Min proteins propagate in waves on the cell membrane, resulting in oscillations between the cell poles, thus preventing the formation of the division ring everywhere but in the cell centre. The dynamic behaviour of Min proteins has been successfully reconstructed in vitro on supported lipid bilayers (SLBs), reproducing many of the features observed in the cell. However, there has been a marked discrepancy between the speed of propagation of Min protein waves in vitro, compared with the cellular system. A very plausible explanation is the different mobility of proteins on model membranes, compared with the inner membrane of bacteria. To quantitatively demonstrate how membrane diffusion influences Min wave propagation, we compared Min waves on SLBs with free-standing giant unilamellar vesicles (GUV) membranes which display higher fluidity. Intriguingly, the propagation velocity and wavelength on GUVs are three times higher than those reported on supported bilayers, but the wave period is conserved. This suggests that the shorter spatial period of the patterns in vivo might indeed be primarily explained by lower diffusion coefficients of proteins on the bacterial inner membrane. |
|
Paridaen JT, Wilsch-Bräuninger M, Huttner WB
|
Asymmetric inheritance of centrosome-associated primary cilium membrane directs ciliogenesis after cell division.
|
Cell 2013 Oct 10;155(2):333-44
|
|
Neurobiology
|

|
24120134 |
|
Primary cilia are key sensory organelles that are thought to be disassembled prior to mitosis. Inheritance of the mother centriole, which nucleates the primary cilium, in relation to asymmetric daughter cell behavior has previously been studied. However, the fate of the ciliary membrane upon cell division is unknown. Here, we followed the ciliary membrane in dividing embryonic neocortical stem cells and cultured cells. Ciliary membrane attached to the mother centriole was endocytosed at mitosis onset, persisted through mitosis at one spindle pole, and was asymmetrically inherited by one daughter cell, which retained stem cell character. This daughter re-established a primary cilium harboring an activated signal transducer earlier than the noninheriting daughter. Centrosomal association of ciliary membrane in dividing neural stem cells decreased at late neurogenesis when these cells differentiate. Our data imply that centrosome-associated ciliary membrane acts as a determinant for the temporal-spatial control of ciliogenesis. |
|
Biro M, Romeo Y, Kroschwald S, Bovellan M, Boden A, Tcherkezian J, Roux PP, Charras G, Paluch EK
|
Cell cortex composition and homeostasis resolved by integrating proteomics and quantitative imaging.
|
Cytoskeleton (Hoboken) 2013 Nov 17;70(11):741-54
|
|
Cell Biology
|

|
24136886 |
actin assembly; actin cortex; blebs; proteomics; quantitative imaging |
The cellular actin cortex is the cytoskeletal structure primarily responsible for the control of animal cell shape and as such plays a central role in cell division, migration, and tissue morphogenesis. Due to the lack of experimental systems where the cortex can be investigated independently from other organelles, little is known about its composition, assembly, and homeostasis. Here, we describe novel tools to resolve the composition and regulation of the cortex. We report and validate a protocol for cortex purification based on the separation of cellular blebs. Mass spectrometry analysis of purified cortices provides a first extensive list of cortical components. To assess the function of identified proteins, we design an automated imaging assay for precise quantification of cortical actomyosin assembly dynamics. We show subtle changes in cortex assembly dynamics upon depletion of the identified cortical component profilin. Our widely applicable integrated method paves the way for systems-level investigations of the actomyosin cortex and its regulation during morphogenesis. |
|
Luz M, Knust E
|
Fluorescently tagged Lin7c is a dynamic marker for polarity maturation in the zebrafish retinal epithelium.
|
Biol Open 2013 Jul 01;2(9):867-71
|
|
Developmental Biology
|

|
24143272 |
Crumbs; Neuroepithelia; Polarity; Retina; Zebrafish |
Development of epithelial cell polarity is a highly dynamic process, and often established by the sequential recruitment of conserved protein complexes, such as the Par or the Crumbs (Crb) complex. However, detailed insights into the refinement of polarity and the formation of the complexes are still lacking. Here, we established fluorescently tagged Lin7c, a core member of the Crb complex, as an ideal tool to follow development of polarity in zebrafish epithelia. We find that in gastrula stages, RFP-Lin7c is found in the cytosol of the enveloping layer, while Pard3-GFP is already polarized at this stage. During development of the retinal epithelium, RFP-Lin7c localization is refined from being cytosolic at 14 hours post fertilization (hpf) to almost entirely apical in cells of the eye cup at 28 hpf. This apical Lin7c localization depends on the Crb complex members Oko meduzy and Nagie oko. Thus, fluorescently tagged Lin7c can be used in a broad range of epithelia to follow polarity maturation in vivo and specifically to elucidate the sequence of events determining Crb complex-mediated polarity. |
|
Ludwig B, Reichel A, Steffen A, Zimerman B, Schally AV, Block NL, Colton CK, Ludwig S, Kersting S, Bonifacio E, Solimena M, Gendler Z, Rotem A, Barkai U, Bornstein SR
|
Transplantation of human islets without immunosuppression.
|
Proc. Natl. Acad. Sci. U.S.A. 2013 Nov 19;110(47):19054-8
|
|
Medical Biology
|

|
24167261 |
immune barrier; oxygenation; ?-cell replacement |
Transplantation of pancreatic islets is emerging as a successful treatment for type-1 diabetes. Its current stringent restriction to patients with critical metabolic lability is justified by the long-term need for immunosuppression and a persistent shortage of donor organs. We developed an oxygenated chamber system composed of immune-isolating alginate and polymembrane covers that allows for survival and function of islets without immunosuppression. A patient with type-1 diabetes received a transplanted chamber and was followed for 10 mo. Persistent graft function in this chamber system was demonstrated, with regulated insulin secretion and preservation of islet morphology and function without any immunosuppressive therapy. This approach may allow for future widespread application of cell-based therapies. |
|
Hoyer B, Bernhardt A, Lode A, Heinemann S, Sewing J, Klinger M, Notbohm H, Gelinsky M
|
Jellyfish collagen scaffolds for cartilage tissue engineering.
|
Acta Biomater 2014 Feb 30;10(2):883-92
|
|
Medical Biology
|

|
24184178 |
Chondrogenic differentiation; Fibril formation; Jellyfish; Marine collagen; Mesenchymal stem cells |
Porous scaffolds were engineered from refibrillized collagen of the jellyfish Rhopilema esculentum for potential application in cartilage regeneration. The influence of collagen concentration, salinity and temperature on fibril formation was evaluated by turbidity measurements and quantification of fibrillized collagen. The formation of collagen fibrils with a typical banding pattern was confirmed by atomic force microscopy and transmission electron microscopy analysis. Porous scaffolds from jellyfish collagen, refibrillized under optimized conditions, were fabricated by freeze-drying and subsequent chemical cross-linking. Scaffolds possessed an open porosity of 98.2%. The samples were stable under cyclic compression and displayed an elastic behavior. Cytotoxicity tests with human mesenchymal stem cells (hMSCs) did not reveal any cytotoxic effects of the material. Chondrogenic markers SOX9, collagen II and aggrecan were upregulated in direct cultures of hMSCs upon chondrogenic stimulation. The formation of typical extracellular matrix components was further confirmed by quantification of sulfated glycosaminoglycans. |
|
Eugster A, Lindner A, Heninger AK, Wilhelm C, Dietz S, Catani M, Ziegler AG, Bonifacio E
|
Measuring T cell receptor and T cell gene expression diversity in antigen-responsive human CD4+ T cells.
|
J. Immunol. Methods 2013 Dec 31;400-401:13-22
|
|
Medical Biology
|

|
24239865 |
Gene expression; Human; T cell receptor; T cells |
T cells have diversity in TCR, epitope recognition, and cytokine production, and can be used for immune monitoring. Furthermore, clonal expansion of TCR families in disease may provide opportunities for TCR-directed therapies. We developed methodology for sequencing expressed genes of TCR alpha and beta chains from single cells and applied this to vaccine (tetanus-toxoid)-responsive CD4(+) T cells. TCR alpha and beta chains were both successfully sequenced in 1309 (43%) of 3038 CD4(+) T cells yielding 677 different receptors. TRAV and TRBV gene usage differed between tetanus-toxoid-responsive and non-responsive cells (p=0.004 and 0.0002), and there was extensive TCR diversity in tetanus-toxoid-responsive cells within individuals. Identical TCRs could be recovered in different samples from the same subject: TCRs identified after booster vaccination were frequent in pre-booster memory T cells (31% of pre-booster TCR), and also identified in pre-booster vaccination naïve cells (6.5%). No TCR was shared between subjects, but tetanus toxoid-responsive cells sharing one of their TCR chains were observed within and between subjects. Coupling single-cell gene expression profiling to TCR sequencing revealed examples of distinct cytokine profiles in cells bearing identical TCR. Novel molecular methodology demonstrates extensive diversity of Ag-responsive CD4(+) T cells within and between individuals. |
|
Aprea J, Prenninger S, Dori M, Ghosh T, Monasor LS, Wessendorf E, Zocher S, Massalini S, Alexopoulou D, Lesche M, Dahl A, Groszer M, Hiller M, Calegari F
|
Transcriptome sequencing during mouse brain development identifies long non-coding RNAs functionally involved in neurogenic commitment.
|
EMBO J. 2013 Dec 11;32(24):3145-60
|
|
Neurobiology
|

|
24240175 |
|
Transcriptome analysis of somatic stem cells and their progeny is fundamental to identify new factors controlling proliferation versus differentiation during tissue formation. Here, we generated a combinatorial, fluorescent reporter mouse line to isolate proliferating neural stem cells, differentiating progenitors and newborn neurons that coexist as intermingled cell populations during brain development. Transcriptome sequencing revealed numerous novel long non-coding (lnc)RNAs and uncharacterized protein-coding transcripts identifying the signature of neurogenic commitment. Importantly, most lncRNAs overlapped neurogenic genes and shared with them a nearly identical expression pattern suggesting that lncRNAs control corticogenesis by tuning the expression of nearby cell fate determinants. We assessed the power of our approach by manipulating lncRNAs and protein-coding transcripts with no function in corticogenesis reported to date. This led to several evident phenotypes in neurogenic commitment and neuronal survival, indicating that our study provides a remarkably high number of uncharacterized transcripts with hitherto unsuspected roles in brain development. Finally, we focussed on one lncRNA, Miat, whose manipulation was found to trigger pleiotropic effects on brain development and aberrant splicing of Wnt7b. Hence, our study suggests that lncRNA-mediated alternative splicing of cell fate determinants controls stem-cell commitment during neurogenesis. |
|
Borg DJ, Weigelt M, Wilhelm C, Gerlach M, Bickle M, Speier S, Bonifacio E, Hommel A
|
Mesenchymal stromal cells improve transplanted islet survival and islet function in a syngeneic mouse model.
|
Diabetologia 2014 Mar 20;57(3):522-31
|
- LMF CMCB
- Screening MPI-CBG
|
Medical Biology
|

|
24253203 |
|
Islet transplantation is used therapeutically in a minority of patients with type 1 diabetes. Successful outcomes are hampered by early islet beta cell loss. The adjuvant co-transplantation of mesenchymal stromal cells (MSCs) has the promise to improve islet transplant outcome. |
|
Sandoval-Guzmán T, Wang H, Khattak S, Schuez M, Roensch K, Nacu E, Tazaki A, Joven A, Tanaka EM, Simon A
|
Fundamental differences in dedifferentiation and stem cell recruitment during skeletal muscle regeneration in two salamander species.
|
Cell Stem Cell 2014 Feb 6;14(2):174-87
|
|
Medical Biology
|

|
24268695 |
|
Salamanders regenerate appendages via a progenitor pool called the blastema. The cellular mechanisms underlying regeneration of muscle have been much debated but have remained unclear. Here we applied Cre-loxP genetic fate mapping to skeletal muscle during limb regeneration in two salamander species, Notophthalmus viridescens (newt) and Ambystoma mexicanum (axolotl). Remarkably, we found that myofiber dedifferentiation is an integral part of limb regeneration in the newt, but not in axolotl. In the newt, myofiber fragmentation results in proliferating, PAX7(-) mononuclear cells in the blastema that give rise to the skeletal muscle in the new limb. In contrast, myofibers in axolotl do not generate proliferating cells, and do not contribute to newly regenerated muscle; instead, resident PAX7(+) cells provide the regeneration activity. Our results therefore show significant diversity in limb muscle regeneration mechanisms among salamanders and suggest that multiple strategies may be feasible for inducing regeneration in other species, including mammals. |
|
Diogo R, Tanaka EM
|
Development of fore- and hindlimb muscles in GFP-transgenic axolotls: morphogenesis, the tetrapod bauplan, and new insights on the forelimb-hindlimb enigma.
|
J. Exp. Zool. B Mol. Dev. Evol. 2014 Feb 03;322(2):106-27
|
|
Developmental Biology
|

|
24302552 |
|
The axolotl is becoming one of the most used model organisms in developmental and regenerative studies but no publication has described in detail the development of its forelimb and hindlimb muscles. We describe and illustrate the ontogeny of these muscles in transgenic axolotls that express GFP in muscle fibers and discuss our results and data previously obtained by us and by other authors about limb regeneration in axolotls and ontogeny in frogs and other tetrapods. Our observations and comparisons: (1) demonstrate radio-ulnar and ventro-dorsal morphogenetic gradients in the order of axolotl forelimb muscle formation and differentiation, while in axolotl hindlimb ontogeny there are only proximo-distal and tibio-fibular gradients; some of the axolotl gradients are therefore different from the ulno-radial/fibulo-tibial fore- and hindlimb and the dorso-ventral hindimb ontogenetic morphogenetic gradients seen in frogs and amniotes such as chickens; (2) provide a potential explanation for the usual presence, in both limbs of taxa from all major tetrapod groups, of more radial/tibial muscles than ulnar/fibular muscles; (3) support the "in-out" developmental mechanism of appendicular muscle formation; (4) offer new insights about the ancestral Bauplan of tetrapod limbs, including the striking similarity of the zeugopodial (forearm/leg) and autopodial (hand/foot) muscles of the two limbs and the ventro-dorsal symmetry of the zeugopodial muscles of a same limb; and (5) provide further evidence to corroborate the hypothesis that these similarities are due to derived homoplastic events that occurred during the fins-limbs transition and not due to forelimb-hindlimb serial homology. |
|
Weber A, Hochmann S, Cimalla P, Gärtner M, Kuscha V, Hans S, Geffarth M, Kaslin J, Koch E, Brand M
|
Characterization of light lesion paradigms and optical coherence tomography as tools to study adult retina regeneration in zebrafish.
|
PLoS ONE 2013 Nov 26;8(11):e80483
|
- EMF & Histo CMCB
- LMF CMCB
|
Neurobiology
|

|
24303018 |
|
Light-induced lesions are a powerful tool to study the amazing ability of photoreceptors to regenerate in the adult zebrafish retina. However, the specificity of the lesion towards photoreceptors or regional differences within the retina are still incompletely understood. We therefore characterized the process of degeneration and regeneration in an established paradigm, using intense white light from a fluorescence lamp on swimming fish (diffuse light lesion). We also designed a new light lesion paradigm where light is focused through a microscope onto the retina of an immobilized fish (focused light lesion). Focused light lesion has the advantage of creating a locally restricted area of damage, with the additional benefit of an untreated control eye in the same animal. In both paradigms, cell death is observed as an immediate early response, and proliferation is initiated around 2 days post lesion (dpl), peaking at 3 dpl. We furthermore find that two photoreceptor subtypes (UV and blue sensitive cones) are more susceptible towards intense white light than red/green double cones and rods. We also observed specific differences within light lesioned areas with respect to the process of photoreceptor degeneration: UV cone debris is removed later than any other type of photoreceptor in light lesions. Unspecific damage to retinal neurons occurs at the center of a focused light lesion territory, but not in the diffuse light lesion areas. We simulated the fish eye optical properties using software simulation, and show that the optical properties may explain the light lesion patterns that we observe. Furthermore, as a new tool to study retinal degeneration and regeneration in individual fish in vivo, we use spectral domain optical coherence tomography. Collectively, the light lesion and imaging assays described here represent powerful tools for studying degeneration and regeneration processes in the adult zebrafish retina. |
|
Diogo R, Murawala P, Tanaka EM
|
Is salamander hindlimb regeneration similar to that of the forelimb? Anatomical and morphogenetic analysis of hindlimb muscle regeneration in GFP-transgenic axolotls as a basis for regenerative and developmental studies.
|
J. Anat. 2014 Apr 10;224(4):459-68
|
|
Medical Biology
|

|
24325444 |
Ambystoma; anatomy; hindlimb; morphogenesis; muscles; regeneration; urodele amphibians |
The axolotl Ambystoma mexicanum is one of the most used model organisms in developmental and regenerative studies because it is commonly said that it can reconstitute a normal and fully functional forelimb/hindlimb after amputation. However, there is not a publication that has described in detail the regeneration of the axolotl hindlimb muscles. Here we describe and illustrate, for the first time, the regeneration of the thigh, leg and foot muscles in transgenic axolotls that express green fluorescent protein in muscle fibers and compare our results with data obtained by us and by other authors about axolotl forelimb regeneration and about fore- and hindlimb ontogeny in axolotls, frogs and other tetrapods. Our observations and comparisons point out that: (1) there are no muscle anomalies in any regenerated axolotl hindlimbs, in clear contrast to our previous study of axolotl forelimb regeneration, where we found muscle anomalies in 43% of the regenerated forelimbs; (2) during axolotl hindlimb regeneration there is a proximo-distal and a tibio-fibular morphogenetic gradient in the order of muscle regeneration and differentiation, but not a ventro-dorsal gradient, whereas our previous studies showed that in axolotl forelimb muscle regeneration there are proximo-distal, radio-ulnar and ventro-dorsal morphogenetic gradients. We discuss the broader implications of these observations for regenerative, evolutionary, developmental and morphogenetic studies. |
|
Fuchs YF, Adler K, Lindner A, Karasinsky A, Wilhelm C, Weigelt M, Balke H, Förtsch K, Mortler-Hildebrandt LF, Harlan DM, Pechhold K, Ziegler AG, Bonifacio E
|
IGRP and insulin vaccination induce CD8+ T cell-mediated autoimmune diabetes in the RIP-CD80GP mouse.
|
Clin. Exp. Immunol. 2014 May;176(2):199-206
|
|
Medical Biology
|

|
24387268 |
antigens/peptides/epitopes; autoimmunity; cytotoxic T cells; diabetes |
Autoimmune diabetes is characterized by autoantigen-specific T cell-mediated destruction of pancreatic islet beta cells, and CD8(+) T cells are key players during this process. We assessed whether the bitransgenic RIP-CD80 x RIP-LCMV-GP (RIP-CD80GP) mice may be a versatile antigen-specific model of inducible CD8(+) T cell-mediated autoimmune diabetes. Antigen-encoding DNA, peptide-loaded dendritic cells and antigen plus incomplete Freund's adjuvant were used for vaccination. Of 14 pancreatic proteins tested by DNA vaccination, murine pre-proinsulin 2 (100% of mice; median time after vaccination, 60 days) and islet-specific glucose-6-phosphatase catalytic subunit-related protein (IGRP) (77%, 58 days) could induce diabetes. Vaccination with DNA encoding for zinc transporter 8, Ia-2, Ia-2?, glutamic acid decarboxylase 67 (Gad67), chromogranin A, insulinoma amyloid polypeptide and homeobox protein Nkx-2.2 induced diabetes development in 25-33% of mice. Vaccination with DNA encoding for Gad65, secretogranin 5, pancreas/duodenum homeobox protein 1 (Pdx1), carboxyl ester lipase, glucagon and control hepatitis B surface antigen (HBsAg) induced diabetes in <20% of mice. Diabetes induction efficiency could be increased by DNA vaccination with a vector encoding a ubiquitin-antigen fusion construct. Diabetic mice had florid T cell islet infiltration. CD8(+) T cell targets of IGRP were identified with a peptide library-based enzyme-linked immunospot assay, and diabetes could also be induced by vaccination with major histocompatibility complex (MHC) class I-restricted IGRP peptides loaded on mature dendritic cells. Vaccination with antigen plus incomplete Freund's adjuvant, which can prevent diabetes in other models, led to rapid diabetes development in the RIP-CD80GP mouse. We conclude that RIP-CD80GP mice are a versatile model of antigen specific autoimmune diabetes and may complement existing mouse models of autoimmune diabetes for evaluating CD8(+) T cell-targeted prevention strategies. |
|
Luz M, Spannl-Müller S, Özhan G, Kagermeier-Schenk B, Rhinn M, Weidinger G, Brand M
|
Dynamic association with donor cell filopodia and lipid-modification are essential features of Wnt8a during patterning of the zebrafish neuroectoderm.
|
PLoS ONE 2014 Jan 10;9(1):e84922
|
|
Developmental Biology
|

|
24427298 |
|
Wnt proteins are conserved signaling molecules that regulate pattern formation during animal development. Many Wnt proteins are post-translationally modified by addition of lipid adducts. Wnt8a provides a crucial signal for patterning the anteroposterior axis of the developing neural plate in vertebrates. However, it is not clear how this protein propagates from its source, the blastoderm margin, to the target cells in the prospective neural plate, and how lipid-modifications might influence Wnt8a propagation and activity. |
|
Kretschmer S, Wolf C, König N, Staroske W, Guck J, Häusler M, Luksch H, Nguyen LA, Kim B, Alexopoulou D, Dahl A, Rapp A, Cardoso MC, Shevchenko A, Lee-Kirsch MA
|
SAMHD1 prevents autoimmunity by maintaining genome stability.
|
Ann. Rheum. Dis. 2015 Mar 20;74(3):e17
|
|
Medical Biology
|

|
24445253 |
Autoimmune Diseases; Autoimmunity; Fibroblasts; Systemic Lupus Erythematosus |
The HIV restriction factor, SAMHD1 (SAM domain and HD domain-containing protein 1), is a triphosphohydrolase that degrades deoxyribonucleoside triphosphates (dNTPs). Mutations in SAMHD1 cause Aicardi-Goutières syndrome (AGS), an inflammatory disorder that shares phenotypic similarity with systemic lupus erythematosus, including activation of antiviral type 1 interferon (IFN). To further define the pathomechanisms underlying autoimmunity in AGS due to SAMHD1 mutations, we investigated the physiological properties of SAMHD1. |
|
Kesavan G, Lieven O, Mamidi A, Öhlin ZL, Johansson JK, Li WC, Lommel S, Greiner TU, Semb H
|
Cdc42/N-WASP signaling links actin dynamics to pancreatic β cell delamination and differentiation.
|
Development 2014 Feb;141(3):685-96
|
|
Developmental Biology
|

|
24449844 |
Beta cell delamination; Cdc42; Differentiation |
Delamination plays a pivotal role during normal development and cancer. Previous work has demonstrated that delamination and epithelial cell movement within the plane of an epithelium are associated with a change in cellular phenotype. However, how this positional change is linked to differentiation remains unknown. Using the developing mouse pancreas as a model system, we show that β cell delamination and differentiation are two independent events, which are controlled by Cdc42/N-WASP signaling. Specifically, we show that expression of constitutively active Cdc42 in β cells inhibits β cell delamination and differentiation. These processes are normally associated with junctional actin and cell-cell junction disassembly and the expression of fate-determining transcription factors, such as Isl1 and MafA. Mechanistically, we demonstrate that genetic ablation of N-WASP in β cells expressing constitutively active Cdc42 partially restores both delamination and β cell differentiation. These findings elucidate how junctional actin dynamics via Cdc42/N-WASP signaling cell-autonomously control not only epithelial delamination but also cell differentiation during mammalian organogenesis. |
|
Sundaramurthy V, Barsacchi R, Chernykh M, Stöter M, Tomschke N, Bickle M, Kalaidzidis Y, Zerial M
|
Deducing the mechanism of action of compounds identified in phenotypic screens by integrating their multiparametric profiles with a reference genetic screen.
|
Nat Protoc 2014 Feb 30;9(2):474-90
|
|
Imaging Technologies Development
|

|
24481274 |
|
Cell-based high-content screens are increasingly used to discover bioactive small molecules. However, identifying the mechanism of action of the selected compounds is a major bottleneck. Here we describe a protocol consisting of experimental and computational steps to identify the cellular pathways modulated by chemicals, and their mechanism of action. The multiparametric profiles from a 'query' chemical screen are used as constraints to select genes with similar profiles from a 'reference' genetic screen. In our case, the query screen is the intracellular survival of mycobacteria and the reference is a genome-wide RNAi screen of endocytosis. The two disparate screens are bridged by an 'intermediate' chemical screen of endocytosis, so that the similarity in the multiparametric profiles between the chemical and the genetic perturbations can generate a testable hypothesis of the cellular pathways modulated by the chemicals. This approach is not assay specific, but it can be broadly applied to various quantitative, multiparametric data sets. Generation of the query system takes 3-6 weeks, and data analysis and integration with the reference data set takes an 3 additional weeks. |
|
Wehner D, Cizelsky W, Vasudevaro MD, Ozhan G, Haase C, Kagermeier-Schenk B, Röder A, Dorsky RI, Moro E, Argenton F, Kühl M, Weidinger G
|
Wnt/β-catenin signaling defines organizing centers that orchestrate growth and differentiation of the regenerating zebrafish caudal fin.
|
Cell Rep 2014 Feb 13;6(3):467-81
|
|
Developmental Biology
|

|
24485658 |
|
Zebrafish regenerate their fins via the formation of a population of progenitor cells, the blastema. Wnt/β-catenin signaling is essential for blastemal cell proliferation and patterning of the overlying epidermis. Yet, we find that β-catenin signaling is neither active in the epidermis nor the majority of the proliferative blastemal cells. Rather, tissue-specific pathway interference indicates that Wnt signaling in the nonproliferative distal blastema is required for cell proliferation in the proximal blastema, and signaling in cells lining the osteoblasts directs osteoblast differentiation. Thus, Wnt signaling regulates epidermal patterning, blastemal cell proliferation, and osteoblast maturation indirectly via secondary signals. Gene expression profiling, chromatin immunoprecipitation, and functional rescue experiments suggest that Wnt/β-catenin signaling acts through Fgf and Bmp signaling to control epidermal patterning, whereas retinoic acid and Hedgehog signals mediate its effects on blastemal cell proliferation. We propose that Wnt signaling orchestrates fin regeneration by defining organizing centers that instruct cellular behaviors of adjacent tissues. |
|
Stenzel D, Wilsch-Bräuninger M, Wong FK, Heuer H, Huttner WB
|
Integrin αvβ3 and thyroid hormones promote expansion of progenitors in embryonic neocortex.
|
Development 2014 Feb;141(4):795-806
|
|
Neurobiology
|

|
24496617 |
Cortical neurogenesis; Integrins; Mouse; Thyroid hormones |
Neocortex expansion during evolution is associated with the enlargement of the embryonic subventricular zone, which reflects an increased self-renewal and proliferation of basal progenitors. In contrast to human, the vast majority of mouse basal progenitors lack self-renewal capacity, possibly due to lack of a basal process contacting the basal lamina and downregulation of cell-autonomous production of extracellular matrix (ECM) constituents. Here we show that targeted activation of the ECM receptor integrin αvβ3 on basal progenitors in embryonic mouse neocortex promotes their expansion. Specifically, integrin αvβ3 activation causes an increased cell cycle re-entry of Pax6-negative, Tbr2-positive intermediate progenitors, rather than basal radial glia, and a decrease in the proportion of intermediate progenitors committed to neurogenic division. Interestingly, integrin αvβ3 is the only known cell surface receptor for thyroid hormones. Remarkably, tetrac, a thyroid hormone analog that inhibits the binding of thyroid hormones to integrin αvβ3, completely abolishes the intermediate progenitor expansion observed upon targeted integrin αvβ3 activation, indicating that this expansion requires the binding of thyroid hormones to integrin αvβ3. Convergence of ECM and thyroid hormones on integrin αvβ3 thus appears to be crucial for cortical progenitor proliferation and self-renewal, and hence for normal brain development and the evolutionary expansion of the neocortex. |
|
Economopoulou M, Masjkur J, Raiskup F, Ebermann D, Saha S, Karl MO, Funk R, Jaszai J, Chavakis T, Ehrhart-Bornstein M, Pillunat LE, Kunz-Schughart L, Kurth I, Dubrovska A, Androutsellis-Theotokis A
|
Expression of the transcription factor Hes3 in the mouse and human ocular surface, and in pterygium.
|
Int. J. Radiat. Biol. 2014 Aug 25;90(8):700-9
|
|
Cell Biology
|

|
24512568 |
Hes3; conjunctiva; eye; irradiation; neural stem cells; pterygium |
In this work we examined the presence of the neural stem cell biomarker Hairy and Enhancer of Split 3 (Hes3) in the anterior eye segment and in the aberrant growth condition of the conjunctiva pterygium. Further, we studied the response of Hes3 to irradiation. |
|
Bledau AS, Schmidt K, Neumann K, Hill U, Ciotta G, Gupta A, Torres DC, Fu J, Kranz A, Stewart AF, Anastassiadis K
|
The H3K4 methyltransferase Setd1a is first required at the epiblast stage, whereas Setd1b becomes essential after gastrulation.
|
Development 2014 Mar;141(5):1022-35
|
|
Developmental Biology
|

|
24550110 |
ESC; H3K4 methylation; Reprogramming; Setd1a; Setd1b |
Histone 3 lysine 4 (H3K4) methylation is a universal epigenetic mark. In mammals, there are six H3K4 methyltransferases related to yeast Set1 and fly Trithorax, including two orthologs of Set1: Setd1a and Setd1b. Here we show that mouse Setd1a is required for gastrulation, whereas Setd1b-deficient embryos survive to E11.5 but are grossly retarded. Setd1a knockout embryos implant but do not proceed past the epiblast. Furthermore, Setd1a is not required until the inner cell mass has formed, at which stage it has replaced Mll2 as the major H3K4 methyltransferase. Setd1a is required for embryonic, epiblast and neural stem cell survival and neural stem cell reprogramming, whereas Setd1b is dispensable. Deletion of Setd1a in embryonic stem cells resulted in rapid losses of bulk H3K4 methylation, pluripotency gene expression and proliferation, with G1 pileup. Setd1b overexpression could not rescue the proliferation defects caused by loss of Setd1a in embryonic stem cells. The precise developmental requirement for Setd1a suggests that gastrulation is regulated by a switch between the major H3K4 methyltransferases. |
|
Kujawski S, Lin W, Kitte F, Börmel M, Fuchs S, Arulmozhivarman G, Vogt S, Theil D, Zhang Y, Antos CL
|
Calcineurin regulates coordinated outgrowth of zebrafish regenerating fins.
|
Dev. Cell 2014 Mar 10;28(5):573-87
|
|
Cell Biology
|

|
24561038 |
|
Vertebrates develop organs and appendages in a proportionally coordinated manner, and animals that regenerate them do so to the same dimensions as the original structures. Coordinated proportional growth involves controlled regulation between allometric and isometric growth programs, but it is unclear what executes this control. We show that calcineurin inhibition results in continued allometric outgrowth of regenerating fins beyond their original dimensions. Calcineurin inhibition also maintains allometric growth of juvenile fins and induces it in adult fins. Furthermore, calcineurin activity is low when the regeneration rate is highest, and its activity increases as the rate decreases. Growth measurements and morphometric analysis of proximodistal asymmetry indicate that calcineurin inhibition shifts fin regeneration from a distal growth program to a proximal program. This shift is associated with the promotion of retinoic acid signaling. Thus, we identified a calcineurin-mediated mechanism that operates as a molecular switch between position-associated isometric and allometric growth programs. |
|
Penkov S, Ogawa A, Schmidt U, Tate D, Zagoriy V, Boland S, Gruner M, Vorkel D, Verbavatz JM, Sommer RJ, Knölker HJ, Kurzchalia TV
|
A wax ester promotes collective host finding in the nematode Pristionchus pacificus.
|
Nat. Chem. Biol. 2014 Apr 02;10(4):281-5
|
|
Cell Biology
|

|
24584102 |
|
Survival of nematode species depends on how successfully they disperse in the habitat and find a new host. As a new strategy for collective host finding in the nematode Pristionchus pacificus, dauer larvae synthesize an extremely long-chain polyunsaturated wax ester (nematoil) that covers the surface of the animal. The oily coat promotes congregation of up to one thousand individuals into stable 'dauer towers' that can reach a beetle host more easily. |
|
Redemann S, Weber B, Möller M, Verbavatz JM, Hyman AA, Baum D, Prohaska S, Müller-Reichert T
|
The segmentation of microtubules in electron tomograms using Amira.
|
Methods Mol. Biol. 2014;1136:261-78
|
- EMF MPI-CBG
- LMF & EMF CFCI
|
Image Processing
|

|
24633801 |
|
The development of automatic tools for the three-dimensional reconstruction of the microtubule cytoskeleton is crucial for large-scale analysis of mitotic spindles. Recently, we have published a method for the semiautomatic tracing of microtubules based on 3D template matching (Weber et al., J Struct Biol 178:129-138, 2012). Here, we give step-by-step instructions for the automatic tracing of microtubules emanating from centrosomes in the early mitotic Caenorhabditis elegans embryo. This approach, integrated in the visualization and data analysis software Amira, is applicable to tomographic data sets from other model systems. |
|
Perike S, Özkucur N, Sharma P, Staroske W, Bläsche R, Barth K, Funk RH
|
Phospho-NHE3 forms membrane patches and interacts with beta-actin to sense and maintain constant direction during cell migration.
|
Exp. Cell Res. 2014 May 15;324(1):13-29
|
|
Cell Biology
|

|
24657527 |
Cell membrane potential; Constant direction; Electrotaxis; FCCS; Front-rear polarity; Ion exchange |
The Na(+)/H(+) exchanger NHE3 colocalizes with beta-actin at the leading edge of directionally migrating cells. Using human osteosarcoma cells (SaOS-2), rat osteoblasts (calvaria), and human embryonic kidney (HEK) cells, we identified a novel role for NHE3 via beta-actin in anode and cathode directed motility, during electrotaxis. NHE3 knockdown by RNAi revealed that NHE3 expression is required to achieve constant directionality and polarity in migrating cells. Phosphorylated NHE3 (pNHE3) and beta-actin complex formation was impaired by the NHE3 inhibitor S3226 (IC50 0.02µM). Fluorescence cross-correlation spectroscopy (FCCS) revealed that the molecular interactions between NHE3 and beta-actin in membrane protrusions increased 1.7-fold in the presence of a directional cue and decreased 3.3-fold in the presence of cytochalasin D. Data from flow cytometric analysis showed that membrane potential of cells (Vmem) decreases in directionally migrating, NHE3-deficient osteoblasts and osteosarcoma cells whereas only Vmem of wild type osteoblasts is affected during directional migration. These findings suggest that pNHE3 has a mechanical function via beta-actin that is dependent on its physiological activity and Vmem. Furthermore, phosphatidylinositol 3,4,5-trisphosphate (PIP3) levels increase while PIP2 remains stable when cells have persistent directionality. Both PI3 kinase (PI3K) and Akt expression levels change proportionally to NHE3 levels. Interestingly, however, the content of pNHE3 level does not change when PI3K/Akt is inhibited. Therefore, we conclude that NHE3 can act as a direction sensor for cells and that NHE3 phosphorylation in persistent directional cell migration does not involve PI3K/Akt during electrotaxis. |
|
Weber IP, Ramos AP, Strzyz PJ, Leung LC, Young S, Norden C
|
Mitotic position and morphology of committed precursor cells in the zebrafish retina adapt to architectural changes upon tissue maturation.
|
Cell Rep 2014 Apr 24;7(2):386-97
|
|
Developmental Biology
|

|
24703843 |
|
The development of complex neuronal tissues like the vertebrate retina requires the tight orchestration of cell proliferation and differentiation. Although the complexity of transcription factors and signaling pathways involved in retinogenesis has been studied extensively, the influence of tissue maturation itself has not yet been systematically explored. Here, we present a quantitative analysis of mitotic events during zebrafish retinogenesis that reveals three types of committed neuronal precursors in addition to the previously known apical progenitors. The identified precursor types present at distinct developmental stages and exhibit different mitotic location (apical versus nonapical), cleavage plane orientation, and morphology. Interestingly, the emergence of nonapically dividing committed bipolar cell precursors can be linked to an increase in apical crowding caused by the developing photoreceptor cell layer. Furthermore, genetic interference with neuronal subset specification induces ectopic divisions of committed precursors, underlining the finding that progressing morphogenesis can effect precursor division position. |
|
Gurudev N, Yuan M, Knust E
|
chaoptin, prominin, eyes shut and crumbs form a genetic network controlling the apical compartment of Drosophila photoreceptor cells.
|
Biol Open 2014 Apr 04;3(5):332-41
|
|
Cell Biology
|

|
24705015 |
Adhesion; Microvilli; Retinal degeneration; Rhabdomere |
The apical surface of epithelial cells is often highly specialised to fulfil cell type-specific functions. Many epithelial cells expand their apical surface by forming microvilli, actin-based, finger-like membrane protrusions. The apical surface of Drosophila photoreceptor cells (PRCs) forms tightly packed microvilli, which are organised into the photosensitive rhabdomeres. As previously shown, the GPI-anchored adhesion protein Chaoptin is required for the stability of the microvilli, whereas the transmembrane protein Crumbs is essential for proper rhabdomere morphogenesis. Here we show that chaoptin synergises with crumbs to ensure optimal rhabdomere width. In addition, reduction of crumbs ameliorates morphogenetic defects observed in PRCs mutant for prominin and eyes shut, known antagonists of chaoptin. These results suggest that these four genes provide a balance of adhesion and anti-adhesion to maintain microvilli development and maintenance. Similar to crumbs mutant PRCs, PRCs devoid of prominin or eyes shut undergo light-dependent retinal degeneration. Given the observation that human orthologues of crumbs, prominin and eyes shut result in progressive retinal degeneration and blindness, the Drosophila eye is ideally suited to unravel the genetic and cellular mechanisms that ensure morphogenesis of PRCs and their maintenance under light-mediated stress. |
|
Petkovic M, Jemaiel A, Daste F, Specht CG, Izeddin I, Vorkel D, Verbavatz JM, Darzacq X, Triller A, Pfenninger KH, Tareste D, Jackson CL, Galli T
|
The SNARE Sec22b has a non-fusogenic function in plasma membrane expansion.
|
Nat. Cell Biol. 2014 May 06;16(5):434-44
|
|
Cell Biology
|

|
24705552 |
|
Development of the nervous system requires extensive axonal and dendritic growth during which neurons massively increase their surface area. Here we report that the endoplasmic reticulum (ER)-resident SNARE Sec22b has a conserved non-fusogenic function in plasma membrane expansion. Sec22b is closely apposed to the plasma membrane SNARE syntaxin1. Sec22b forms a trans-SNARE complex with syntaxin1 that does not include SNAP23/25/29, and does not mediate fusion. Insertion of a long rigid linker between the SNARE and transmembrane domains of Sec22b extends the distance between the ER and plasma membrane, and impairs neurite growth but not the secretion of VSV-G. In yeast, Sec22 interacts with lipid transfer proteins, and inhibition of Sec22 leads to defects in lipid metabolism at contact sites between the ER and plasma membrane. These results suggest that close apposition of the ER and plasma membrane mediated by Sec22 and plasma membrane syntaxins generates a non-fusogenic SNARE bridge contributing to plasma membrane expansion, probably through non-vesicular lipid transfer. |
|
Heymann MC, Winkler S, Luksch H, Flecks S, Franke M, Ruß S, Ozen S, Yilmaz E, Klein C, Kallinich T, Lindemann D, Brenner S, Ganser G, Roesler J, Rösen-Wolff A, Hofmann SR
|
Human procaspase-1 variants with decreased enzymatic activity are associated with febrile episodes and may contribute to inflammation via RIP2 and NF-κB signaling.
|
J. Immunol. 2014 May 1;192(9):4379-85
|
|
Cell Biology
|

|
24706726 |
|
The proinflammatory enzyme caspase-1 plays an important role in the innate immune system and is involved in a variety of inflammatory conditions. Rare naturally occurring human variants of the caspase-1 gene (CASP1) lead to different protein expression and structure and to decreased or absent enzymatic activity. Paradoxically, a significant number of patients with such variants suffer from febrile episodes despite decreased IL-1β production and secretion. In this study, we investigate how variant (pro)caspase-1 can possibly contribute to inflammation. In a transfection model, such variant procaspase-1 binds receptor interacting protein kinase 2 (RIP2) via Caspase activation and recruitment domain (CARD)/CARD interaction and thereby activates NF-κB, whereas wild-type procaspase-1 reduces intracellular RIP2 levels by enzymatic cleavage and release into the supernatant. We approach the protein interactions by coimmunoprecipitation and confocal microscopy and show that NF-κB activation is inhibited by anti-RIP2-short hairpin RNA and by the expression of a RIP2 CARD-only protein. In conclusion, variant procaspase-1 binds RIP2 and thereby activates NF-κB. This pathway could possibly contribute to proinflammatory signaling. |
|
Arumugam S, Petrašek Z, Schwille P
|
MinCDE exploits the dynamic nature of FtsZ filaments for its spatial regulation.
|
Proc. Natl. Acad. Sci. U.S.A. 2014 Apr 1;111(13):E1192-200
|
|
Biophysics
|

|
24707052 |
bacterial cytoskeleton; cell division; depolymerization; self-organization |
In Escherichia coli, a contractile ring (Z-ring) is formed at midcell before cytokinesis. This ring consists primarily of FtsZ, a tubulin-like GTPase, that assembles into protofilaments similar to those in microtubules but different in their suprastructures. The Min proteins MinC, MinD, and MinE are determinants of Z-ring positioning in E. coli. MinD and MinE oscillate from pole to pole, and genetic and biochemical evidence concludes that MinC positions the Z-ring by coupling its assembly to the oscillations by direct inhibitory interaction. The mechanism of inhibition of FtsZ polymerization and, thus, positioning by MinC, however, is not understood completely. Our in vitro reconstitution experiments suggest that the Z-ring consists of dynamic protofilament bundles in which monomers constantly are exchanged throughout, stochastically creating protofilament ends along the length of the filament. From the coreconstitution of FtsZ with MinCDE, we propose that MinC acts on the filaments in two ways: by increasing the detachment rate of FtsZ-GDP within the filaments and by reducing the attachment rate of FtsZ monomers to filaments by occupying binding sites on the FtsZ filament lattice. Furthermore, our data show that the MinCDE system indeed is sufficient to cause spatial regulation of FtsZ, required for Z-ring positioning. |
|
Kumichel A, Knust E
|
Apical localisation of crumbs in the boundary cells of the Drosophila hindgut is independent of its canonical interaction partner stardust.
|
PLoS ONE 2014 Apr 07;9(4):e94038
|
|
Cell Biology
|

|
24710316 |
|
The transmembrane protein Crumbs/Crb is a key regulator of apico-basal epithelial cell polarity, both in Drosophila and in vertebrates. In most cases studied so far, the apical localisation of Drosophila Crumbs depends on the interaction of its C-terminal amino acids with the scaffolding protein Stardust. Consequently, embryos lacking either Crumbs or Stardust develop a very similar phenotype, characterised by the loss of epithelial tissue integrity and cell polarity in many epithelia. An exception is the hindgut, which is not affected by the loss of either gene. The hindgut is a single layered epithelial tube composed of two cell populations, the boundary cells and the principal cells. Here we show that Crumbs localisation in the principal cells depends on Stardust, similarly to other embryonic epithelia. In contrast, localisation of Crumbs in the boundary cells does not require Stardust and is independent of its PDZ domain- and FERM-domain binding motifs. In line with this, the considerable upregulation of Crumbs in boundary cells is not followed by a corresponding upregulation of its canonical binding partners. Our data are the first to suggest a mechanism controlling apical Crumbs localisation, which is independent of its conserved FERM- and PDZ-domain binding motifs. |
|
Baumgärtner S, Tolić IM
|
Astral microtubule pivoting promotes their search for cortical anchor sites during mitosis in budding yeast.
|
PLoS ONE 2014 Apr 10;9(4):e93781
|
|
Biophysics
|

|
24721997 |
|
Positioning of the mitotic spindle is crucial for proper cell division. In the budding yeast Saccharomyces cerevisiae, two mechanisms contribute to spindle positioning. In the Kar9 pathway, astral microtubules emanating from the daughter-bound spindle pole body interact via the linker protein Kar9 with the myosin Myo2, which moves the microtubule along the actin cables towards the neck. In the dynein pathway, astral microtubules off-load dynein onto the cortical anchor protein Num1, which is followed by dynein pulling on the spindle. Yet, the mechanism by which microtubules target cortical anchor sites is unknown. Here we quantify the pivoting motion of astral microtubules around the spindle pole bodies, which occurs during spindle translocation towards the neck and through the neck. We show that this pivoting is largely driven by the Kar9 pathway. The microtubules emanating from the daughter-bound spindle pole body pivot faster than those at the mother-bound spindle pole body. The Kar9 pathway reduces the time needed for an astral microtubule inside the daughter cell to start pulling on the spindle. Thus, we propose a new role for microtubule pivoting: By pivoting around the spindle pole body, microtubules explore the space laterally, which helps them search for cortical anchor sites in the context of spindle positioning in budding yeast. |
|
Fei JF, Haffner C, Huttner WB
|
3' UTR-dependent, miR-92-mediated restriction of Tis21 expression maintains asymmetric neural stem cell division to ensure proper neocortex size.
|
Cell Rep 2014 Apr 24;7(2):398-411
|
|
Neurobiology
|

|
24726360 |
|
Mammalian neocortex size primarily reflects the number and mode of divisions of neural stem and progenitor cells. Cortical stem cells (apical progenitors) switching from symmetric divisions, which expand their population, to asymmetric divisions, which generate downstream neuronal progenitors (basal progenitors), start expressing Tis21, a so-called antiproliferative/prodifferentiative gene. Tis21 encodes a small (17.5 kDa), functionally poorly characterized protein and a relatively large (2 kb), highly conserved 3' UTR. Here, we show that mice lacking the Tis21 3' UTR develop a microcephalic neocortex with fewer neurons, notably in the upper layers. This reflects a progressive decrease in basal progenitors, which in turn is due to a fraction of apical progenitors prematurely switching from asymmetric self-renewing to symmetric self-consuming divisions. This switch is caused by the markedly increased Tis21 protein level resulting from lack of microRNA-, notably miR-92-, dependent restriction of Tis21 expression. Our data show that a premature onset of consumptive neural stem cell divisions can lead to microcephaly. |
|
Wong FK, Haffner C, Huttner WB, Taverna E
|
Microinjection of membrane-impermeable molecules into single neural stem cells in brain tissue.
|
Nat Protoc 2014 May 24;9(5):1170-82
|
|
Neurobiology
|

|
24762784 |
|
This microinjection protocol allows the manipulation and tracking of neural stem and progenitor cells in tissue at single-cell resolution. We demonstrate how to apply microinjection to organotypic brain slices obtained from mice and ferrets; however, our technique is not limited to mouse and ferret embryos, but provides a means of introducing a wide variety of membrane-impermeable molecules (e.g., nucleic acids, proteins, hydrophilic compounds) into neural stem and progenitor cells of any developing mammalian brain. Microinjection experiments are conducted by using a phase-contrast microscope equipped with epifluorescence, a transjector and a micromanipulator. The procedure normally takes ?2 h for an experienced researcher, and the entire protocol, including tissue processing, can be performed within 1 week. Thus, microinjection is a unique and versatile method for changing and tracking the fate of a cell in organotypic slice culture. |
|
Petrovska I, Nüske E, Munder MC, Kulasegaran G, Malinovska L, Kroschwald S, Richter D, Fahmy K, Gibson K, Verbavatz JM, Alberti S
|
Filament formation by metabolic enzymes is a specific adaptation to an advanced state of cellular starvation.
|
Elife 2014 Apr 25
|
- EMF MPI-CBG
- IPF MPI-CBG
- LMF MPI-CBG
|
Cell Biology
|

|
24771766 |
S. cerevisiae |
One of the key questions in biology is how the metabolism of a cell responds to changes in the environment. In budding yeast, starvation causes a drop in intracellular pH, but the functional role of this pH change is not well understood. Here, we show that the enzyme glutamine synthetase (Gln1) forms filaments at low pH and that filament formation leads to enzymatic inactivation. Filament formation by Gln1 is a highly cooperative process, strongly dependent on macromolecular crowding, and involves back-to-back stacking of cylindrical homo-decamers into filaments that associate laterally to form higher order fibrils. Other metabolic enzymes also assemble into filaments at low pH. Hence, we propose that filament formation is a general mechanism to inactivate and store key metabolic enzymes during a state of advanced cellular starvation. These findings have broad implications for understanding the interplay between nutritional stress, the metabolism and the physical organization of a cell. |
|
Ozkucur N, Song B, Bola S, Zhang L, Reid B, Fu G, Funk RH, Zhao M
|
NHE3 phosphorylation via PKCη marks the polarity and orientation of directionally migrating cells.
|
Cell. Mol. Life Sci. 2014 Dec 01;71(23):4653-63
|
|
Cell Biology
|

|
24788043 |
|
Endogenous electric fields (EF) may provide an overriding cue for directional cell migration during wound closure. Perceiving a constant direction requires active sodium-hydrogen exchanger (pNHE3) at the leading edge of HEK 293 cells but its activation mechanism is not yet fully understood. Because protein kinase C (PKC) is required in electrotaxis, we asked whether NHE3 is activated by PKC during wound healing. Using pharmacological (pseudosubstrate and edelfosine) inhibition, we showed that inhibition of PKCη isoform impairs directional cell migration in HEK 293 cells in the presence of a persistent directional cue (0.25-0.3 V/mm of EF for 2 h). Further, we found that pNHE3 forms complexes with both PKCη and ɣ-tubulin, suggesting that these molecules may regulate the microtubule-organizing center. In addition, cellular pNHE3 content was reduced significantly when PKCη was inhibited during directional cell migration. Taken together, these data suggest that PKCη-dependent phosphorylation of NHE3 and the formation of pNHE3/PKCη/ɣ-tubulin complexes at the leading edge of the cell are required for directional cell migration in an EF. |
|
Steenblock C, Heckel T, Czupalla C, Espírito Santo AI, Niehage C, Sztacho M, Hoflack B
|
The Cdc42 guanine nucleotide exchange factor FGD6 coordinates cell polarity and endosomal membrane recycling in osteoclasts.
|
J. Biol. Chem. 2014 Jun 27;289(26):18347-59
|
|
Cell Biology
|

|
24821726 |
Actin; CDC42; FGD6; Membrane Recycling; Osteoclast; Podosome; Src |
The initial step of bone digestion is the adhesion of osteoclasts onto bone surfaces and the assembly of podosomal belts that segregate the bone-facing ruffled membrane from other membrane domains. During bone digestion, membrane components of the ruffled border also need to be recycled after macropinocytosis of digested bone materials. How osteoclast polarity and membrane recycling are coordinated remains unknown. Here, we show that the Cdc42-guanine nucleotide exchange factor FGD6 coordinates these events through its Src-dependent interaction with different actin-based protein networks. At the plasma membrane, FGD6 couples cell adhesion and actin dynamics by regulating podosome formation through the assembly of complexes comprising the Cdc42-interactor IQGAP1, the Rho GTPase-activating protein ARHGAP10, and the integrin interactors Talin-1/2 or Filamin A. On endosomes and transcytotic vesicles, FGD6 regulates retromer-dependent membrane recycling through its interaction with the actin nucleation-promoting factor WASH. These results provide a mechanism by which a single Cdc42-exchange factor controlling different actin-based processes coordinates cell adhesion, cell polarity, and membrane recycling during bone degradation. |
|
Geurtzen K, Knopf F, Wehner D, Huitema LF, Schulte-Merker S, Weidinger G
|
Mature osteoblasts dedifferentiate in response to traumatic bone injury in the zebrafish fin and skull.
|
Development 2014 Jun 12;141(11):2225-34
|
|
Developmental Biology
|

|
24821985 |
Bone; Dedifferentiation; Fracture; Injury; Kaede; Lepidotrichia; Osteoblast; Osteocalcin; Skull; Zebrafish |
Zebrafish have an unlimited capacity to regenerate bone after fin amputation. In this process, mature osteoblasts dedifferentiate to osteogenic precursor cells and thus represent an important source of newly forming bone. By contrast, differentiated osteoblasts do not appear to contribute to repair of bone injuries in mammals; rather, osteoblasts form anew from mesenchymal stem cells. This raises the question whether osteoblast dedifferentiation is specific to appendage regeneration, a special feature of the lepidotrichia bone of the fish fin, or a process found more generally in fish bone. Here, we show that dedifferentiation of mature osteoblasts is not restricted to fin regeneration after amputation, but also occurs during repair of zebrafish fin fractures and skull injuries. In both models, mature osteoblasts surrounding the injury downregulate the expression of differentiation markers, upregulate markers of the pre-osteoblast state and become proliferative. Making use of photoconvertible Kaede protein as well as Cre-driven genetic fate mapping, we show that osteoblasts migrate to the site of injury to replace damaged tissue. Our findings suggest a fundamental role for osteoblast dedifferentiation in reparative bone formation in fish and indicate that adult fish osteoblasts display elevated cellular plasticity compared with mammalian bone-forming cells. |
|
Masjkur J, Levenfus I, Lange S, Arps-Forker C, Poser S, Qin N, Vukicevic V, Chavakis T, Eisenhofer G, Bornstein SR, Ehrhart-Bornstein M, Androutsellis-Theotokis A
|
A defined, controlled culture system for primary bovine chromaffin progenitors reveals novel biomarkers and modulators.
|
Stem Cells Transl Med 2014 Jul 22;3(7):801-8
|
|
Cell Biology
|

|
24855275 |
Cell culture; Differentiation; Self-renewal; Signal transduction |
We present a method to efficiently culture primary chromaffin progenitors from the adult bovine adrenal medulla in a defined, serum-free monolayer system. Tissue is dissociated and plated for expansion under support by the mitogen basic fibroblast growth factor (bFGF). The cultures, although not homogenous, contain a subpopulation of cells expressing the neural stem cell marker Hes3 that also propagate. In addition, Hes3 is also expressed in the adult adrenal medulla from where the tissue is taken. Differentiation is induced by bFGF withdrawal and switching to Neurobasal medium containing B27. Following differentiation, Hes3 expression is lost, and cells acquire morphologies and biomarker expression patterns of chromaffin cells and dopaminergic neurons. We tested the effect of different treatments that we previously showed regulate Hes3 expression and cell number in cultures of fetal and adult rodent neural stem cells. Treatment of the cultures with a combination of Delta4, Angiopoietin2, and a Janus kinase inhibitor increases cell number during the expansion phase without significantly affecting catecholamine content levels. Treatment with cholera toxin does not significantly affect cell number but reduces the ratio of epinephrine to norepinephrine content and increases the dopamine content relative to total catecholamines. These data suggest that this defined culture system can be used for target identification in drug discovery programs and that the transcription factor Hes3 may serve as a new biomarker of putative adrenomedullary chromaffin progenitor cells. |
|
Visco I, Chiantia S, Schwille P
|
Asymmetric supported lipid bilayer formation via methyl-β-cyclodextrin mediated lipid exchange: influence of asymmetry on lipid dynamics and phase behavior.
|
Langmuir 2014 Jul 1;30(25):7475-84
|
|
Biophysics
|

|
24885372 |
|
Supported lipid bilayers (SLBs) are broadly used as minimal membrane models and commonly produced by vesicle fusion (VF) on solid supports. Despite its advantages, VF does not allow the controlled formation of bilayers that mimic the leaflet asymmetry in lipid composition normally found in biological systems. Here we present a simple, quick, and versatile method to produce SLBs with a desired asymmetric lipid composition which is stable for ca. 4 h. We apply methyl-β-cyclodextrin mediated lipid exchange to SLBs formed by VF to enrich the upper leaflet of the bilayer with sphingomyelin. The bilayer asymmetry is assessed by fluorescence correlation spectroscopy, measuring the lipid mobility separately in each leaflet. To check the compatibility of the method with the most common protein reconstitution approaches, we report the production of asymmetric SLBs (aSLBs) in the presence of a glycosylphosphatidylinositol-anchored protein, reconstituted in the bilayer both, via direct protein insertion, and via proteoliposomes fusion. We finally apply aSLBs to study phase separation and transbilayer lipid movement of raft-mimicking lipid mixtures. The observed differences in terms of phase separation in symmetric and asymmetric SLBs with the same overall lipid composition provide further experimental evidence that the transversal lipid distribution affects the overall lipid miscibility and allow to temporally investigate leaflet mixing. |
|
Aprea J, Nonaka-Kinoshita M, Calegari F
|
Generation and characterization of Neurod1-CreER(T2) mouse lines for the study of embryonic and adult neurogenesis.
|
Genesis 2014 Oct 23;52(10):870-8
|
|
Neurobiology
|

|
24913893 |
CNS development; CreERT2; Neurod1; adult neurogenesis |
Neurod1 is a transcription factor involved in several developmental programs of the gastrointestinal tract, pancreas, neurosensory, and central nervous system. In the brain, Neurod1 has been shown to be essential for neurogenesis as well as migration, maturation, and survival of newborn neurons during development and adulthood. Interestingly, Neurod1 expression is maintained in a subset of fully mature neurons where its function remains unclear. To study the role of Neurod1, systems are required that allow the temporal and spatial genetic manipulation of Neurod1-expressing cells. To this aim, we have generated four Neurod1-CreER(T2) mouse lines in which CreER(T2) expression, although at different levels, is restricted within areas of physiological Neurod1 expression and Neurod1 positive cells. In particular, the different levels of CreER(T2) expression in different mouse lines offers the opportunity to select the one that is more suited for a given experimental approach. Hence, our Neurod1-CreER(T2) lines provide valuable new tools for the manipulation of newborn neurons during development and adulthood as well as for studying the subpopulation of mature neurons that retain Neurod1 expression throughout life. In this context, we here report that Neurod1 is not only expressed in immature newborn neurons of the adult hippocampus, as already described, but also in fully mature granule cells of the dentate gyrus. |
|
Bernhardt A, Schumacher M, Gelinsky M
|
Formation of osteoclasts on calcium phosphate bone cements and polystyrene depends on monocyte isolation conditions.
|
Tissue Eng Part C Methods 2015 Feb 22;21(2):160-70
|
|
Medical Biology
|

|
24919531 |
|
Peripheral blood mononuclear cells (PBMC) are an attractive source for the generation of osteoclasts in vitro, which is an important prerequisite for the examination of resorption and remodeling of biomaterials. In this study, different preparation methods are used to obtain cell populations with a rising content of CD14(+) monocytes. We wanted to address the question whether there is a correlation between content of CD14(+) cells in the preparation and functionality of formed osteoclasts. |
|
Swierczynska MM, Mateska I, Peitzsch M, Bornstein SR, Chavakis T, Eisenhofer G, Lamounier-Zepter V, Eaton S
|
Changes in morphology and function of adrenal cortex in mice fed a high-fat diet.
|
Int J Obes (Lond) 2015 Feb 12;39(2):321-30
|
|
Cell Biology
|

|
24919565 |
|
Obesity is a major risk factor for the development of type 2 diabetes and other debilitating diseases. Obesity and diabetes are intimately linked with altered levels of adrenal steroids. Elevated levels of these hormones induce insulin resistance and cause cardiovascular diseases. The mechanisms underlying obesity-related alterations in adrenal steroids are still not well understood. Here, we investigated how diet-induced obesity affects the morphology and function of the mouse adrenal cortex. |
|
Coelho M, Lade SJ, Alberti S, Gross T, Tolić IM
|
Fusion of protein aggregates facilitates asymmetric damage segregation.
|
PLoS Biol. 2014 Jun 17;12(6):e1001886
|
|
Cell Biology
|

|
24936793 |
|
Asymmetric segregation of damaged proteins at cell division generates a cell that retains damage and a clean cell that supports population survival. In cells that divide asymmetrically, such as Saccharomyces cerevisiae, segregation of damaged proteins is achieved by retention and active transport. We have previously shown that in the symmetrically dividing Schizosaccharomyces pombe there is a transition between symmetric and asymmetric segregation of damaged proteins. Yet how this transition and generation of damage-free cells are achieved remained unknown. Here, by combining in vivo imaging of Hsp104-associated aggregates, a form of damage, with mathematical modeling, we find that fusion of protein aggregates facilitates asymmetric segregation. Our model predicts that, after stress, the increased number of aggregates fuse into a single large unit, which is inherited asymmetrically by one daughter cell, whereas the other one is born clean. We experimentally confirmed that fusion increases segregation asymmetry, for a range of stresses, and identified Hsp16 as a fusion factor. Our work shows that fusion of protein aggregates promotes the formation of damage-free cells. Fusion of cellular factors may represent a general mechanism for their asymmetric segregation at division. |
|
Zieske K, Schweizer J, Schwille P
|
Surface topology assisted alignment of Min protein waves.
|
FEBS Lett. 2014 Aug 1;588(15):2545-9
|
|
Biophysics
|

|
24937143 |
Diffusion–reaction mechanism; MinD; MinE; Pattern formation; Self-organization |
Self-organization of proteins into large-scale structures is of pivotal importance for the organization of cells. The Min protein system of the bacterium Escherichia coli is a prime example of how pattern formation occurs via reaction-diffusion. We have previously demonstrated how Min protein patterns are influenced by compartment geometry. Here we probe the influence of membrane surface topology, as an additional regulatory element. Using microstructured membrane-clad soft polymer substrates, Min protein patterns can be aligned. We demonstrate that Min pattern alignment starts early during pattern formation and show that macroscopic millimeter-sized areas of protein patterns of well-defined orientation can be generated. |
|
Konantz J, Antos CL
|
Reverse genetic morpholino approach using cardiac ventricular injection to transfect multiple difficult-to-target tissues in the zebrafish larva.
|
J Vis Exp 2014 Jun 17;(88)
|
|
Developmental Biology
|

|
24961304 |
|
The zebrafish is an important model to understand the cell and molecular biology of organ and appendage regeneration. However, molecular strategies to employ reverse genetics have not yet been adequately developed to assess gene function in regeneration or tissue homeostasis during larval stages after zebrafish embryogenesis, and several tissues within the zebrafish larva are difficult to target. Intraventricular injections of gene-specific morpholinos offer an alternative method for the current inability to genomically target zebrafish genes in a temporally controlled manner at these stages. This method allows for complete dispersion and subsequent incorporation of the morpholino into various tissues throughout the body, including structures that were formerly impossible to reach such as those in the larval caudal fin, a structure often used to noninvasively research tissue regeneration. Several genes activated during larval finfold regeneration are also present in regenerating adult vertebrate tissues, so the larva is a useful model to understand regeneration in adults. This morpholino dispersion method allows for the quick and easy identification of genes required for the regeneration of larval tissues as well as other physiological phenomena regulating tissue homeostasis after embryogenesis. Therefore, this delivery method provides a currently needed strategy for temporal control to the evaluation of gene function after embryogenesis. |
|
Mora-Bermúdez F, Matsuzaki F, Huttner WB
|
Specific polar subpopulations of astral microtubules control spindle orientation and symmetric neural stem cell division.
|
Elife 2014 Jul 04;3
|
|
Cell Biology
|

|
24996848 |
astral microtubules; asymmetric cell division; cell biology; developmental biology; mouse; neural stem cells; neurogenesis; nocodazole; spindle orientation; stem cells |
Mitotic spindle orientation is crucial for symmetric vs asymmetric cell division and depends on astral microtubules. Here, we show that distinct subpopulations of astral microtubules exist, which have differential functions in regulating spindle orientation and division symmetry. Specifically, in polarized stem cells of developing mouse neocortex, astral microtubules reaching the apical and basal cell cortex, but not those reaching the central cell cortex, are more abundant in symmetrically than asymmetrically dividing cells and reduce spindle orientation variability. This promotes symmetric divisions by maintaining an apico-basal cleavage plane. The greater abundance of apical/basal astrals depends on a higher concentration, at the basal cell cortex, of LGN, a known spindle-cell cortex linker. Furthermore, newly developed specific microtubule perturbations that selectively decrease apical/basal astrals recapitulate the symmetric-to-asymmetric division switch and suffice to increase neurogenesis in vivo. Thus, our study identifies a novel link between cell polarity, astral microtubules, and spindle orientation in morphogenesis. |
|
Knoch KP, Nath-Sain S, Petzold A, Schneider H, Beck M, Wegbrod C, Sönmez A, Münster C, Friedrich A, Roivainen M, Solimena M
|
PTBP1 is required for glucose-stimulated cap-independent translation of insulin granule proteins and Coxsackieviruses in beta cells.
|
Mol Metab 2014 Aug 14;3(5):518-30
|
|
Medical Biology
|

|
25061557 |
Beta cells; CV, Coxsackievirus; Diabetes; ER, endoplasmic reticulum; EV, Enterovirus; F, Faulkner; FL, firefly luciferase; IRES, internal ribosomal entry site; ITAF, IRES-trans-acting factor; Insulin; MCA, MIN6 cell adapted; PABP, poly(A)-binding protein; |
Glucose and GLP-1 stimulate not only insulin secretion, but also the post-transcriptional induction of insulin granule biogenesis. This process involves the nucleocytoplasmic translocation of the RNA binding protein PTBP1. Binding of PTBP1 to the 3'-UTRs of mRNAs for insulin and other cargoes of beta cell granules increases their stability. Here we show that glucose enhances also the binding of PTBP1 to the 5'-UTRs of these transcripts, which display IRES activity, and their translation exclusively in a cap-independent fashion. Accordingly, glucose-induced biosynthesis of granule cargoes was unaffected by pharmacological, genetic or Coxsackievirus-mediated inhibition of cap-dependent translation. Infection with Coxsackieviruses, which also depend on PTBP1 for their own cap-independent translation, reduced instead granule stores and insulin release. These findings provide insight into the mechanism for glucose-induction of insulin granule production and on how Coxsackieviruses, which have been implicated in the pathogenesis of type 1 diabetes, can foster beta cell failure. |
|
Toyoda Y, Erkut C, Pan-Montojo F, Boland S, Stewart MP, Müller DJ, Wurst W, Hyman AA, Kurzchalia TV
|
Products of the Parkinson's disease-related glyoxalase DJ-1, D-lactate and glycolate, support mitochondrial membrane potential and neuronal survival.
|
Biol Open 2014 Jul 25;3(8):777-84
|
|
Cell Biology
|

|
25063200 |
D-lactate; Glycolate; Glyoxalase; Mitochondrial membrane potential; Parkinson's disease |
Parkinson's disease is associated with mitochondrial decline in dopaminergic neurons of the substantia nigra. One of the genes linked with the onset of Parkinson's disease, DJ-1/PARK7, belongs to a novel glyoxalase family and influences mitochondrial activity. It has been assumed that glyoxalases fulfill this task by detoxifying aggressive aldehyde by-products of metabolism. Here we show that supplying either D-lactate or glycolate, products of DJ-1, rescues the requirement for the enzyme in maintenance of mitochondrial potential. We further show that glycolic acid and D-lactic acid can elevate lowered mitochondrial membrane potential caused by silencing PINK-1, another Parkinson's related gene, as well as by paraquat, an environmental toxin known to be linked with Parkinson's disease. We propose that DJ-1 and consequently its products are components of a novel pathway that stabilizes mitochondria during cellular stress. We go on to show that survival of cultured mesencephalic dopaminergic neurons, defective in Parkinson's disease, is enhanced by glycolate and D-lactate. Because glycolic and D-lactic acids occur naturally, they are therefore a potential therapeutic route for treatment or prevention of Parkinson's disease. |
|
Umetsu D, Aigouy B, Aliee M, Sui L, Eaton S, Jülicher F, Dahmann C
|
Local increases in mechanical tension shape compartment boundaries by biasing cell intercalations.
|
Curr. Biol. 2014 Aug 4;24(15):1798-805
|
|
Biophysics
|

|
25065753 |
|
Mechanical forces play important roles during tissue organization in developing animals. Many tissues are organized into adjacent, nonmixing groups of cells termed compartments. Boundaries between compartments display a straight morphology and are associated with signaling centers that are important for tissue growth and patterning. Local increases in mechanical tension at cell junctions along compartment boundaries have recently been shown to prevent cell mixing and to maintain straight boundaries. The cellular mechanisms by which local increases in mechanical tension prevent cell mixing at compartment boundaries, however, remain poorly understood. Here, we have used live imaging and quantitative image analysis to determine cellular dynamics at and near the anteroposterior compartment boundaries of the Drosophila pupal abdominal epidermis. We show that cell mixing within compartments involves multiple cell intercalations. Frequency and orientation of cell intercalations are unchanged along the compartment boundaries; rather, an asymmetry in the shrinkage of junctions during intercalation is biased, resulting in cell rearrangements that suppress cell mixing. Simulations of tissue growth show that local increases in mechanical tension can account for this bias in junctional shrinkage. We conclude that local increases in mechanical tension maintain cell populations separate by influencing junctional rearrangements during cell intercalation. |
|
Wueseke O, Bunkenborg J, Hein MY, Zinke A, Viscardi V, Woodruff JB, Oegema K, Mann M, Andersen JS, Hyman AA
|
The Caenorhabditis elegans pericentriolar material components SPD-2 and SPD-5 are monomeric in the cytoplasm before incorporation into the PCM matrix.
|
Mol. Biol. Cell 2014 Oct 1;25(19):2984-92
|
|
Biophysics
|

|
25103243 |
|
Centrosomes are the main microtubule-organizing centers in animal cells. Centrosomes consist of a pair of centrioles surrounded by a matrix of pericentriolar material (PCM) that assembles from cytoplasmic components. In Caenorhabditis elegans embryos, interactions between the coiled-coil proteins SPD-5 and SPD-2 and the kinase PLK-1 are critical for PCM assembly. However, it is not known whether these interactions promote the formation of cytoplasmic complexes that are added to the PCM or whether the components interact only during incorporation into the PCM matrix. Here we address this problem by using a combination of live-cell fluorescence correlation spectroscopy, mass spectrometry, and hydrodynamic techniques to investigate the native state of PCM components in the cytoplasm. We show that SPD-2 is monomeric, and neither SPD-2 nor SPD-5 exists in complex with PLK-1. SPD-5 exists mostly as a monomer but also forms complexes with the PP2A-regulatory proteins RSA-1 and RSA-2, which are required for microtubule organization at centrosomes. These results suggest that the interactions between SPD-2, SPD-5, and PLK-1 do not result in formation of cytoplasmic complexes, but instead occur in the context of PCM assembly. |
|
Carido M, Zhu Y, Postel K, Benkner B, Cimalla P, Karl MO, Kurth T, Paquet-Durand F, Koch E, Münch TA, Tanaka EM, Ader M
|
Characterization of a mouse model with complete RPE loss and its use for RPE cell transplantation.
|
Invest. Ophthalmol. Vis. Sci. 2014 Aug 07;55(8):5431-44
|
|
Medical Biology
|

|
25103259 |
age-related macular degeneration; hESC-derived RPE; retinal pigment epithelium; sodium iodate; transplantation |
Age-related macular degeneration (AMD) is a major leading cause of visual impairment and blindness with no cure currently established. Cell replacement of RPE is discussed as a potential therapy for AMD. Previous studies were performed in animal models with severe limitations in recapitulating the disease progression. In detail, we describe the effect of systemic injection of sodium iodate in the mouse retina. We further evaluate the usefulness of this animal model to analyze cell-specific effects following transplantation of human embryonic stem cell (hESC)-derived RPE cells. |
|
Zarzosa A, Grassme K, Tanaka E, Taniguchi Y, Bramke S, Kurth T, Epperlein H
|
Axolotls with an under- or oversupply of neural crest can regulate the sizes of their dorsal root ganglia to normal levels.
|
Dev. Biol. 2014 Oct 1;394(1):65-82
|
|
Neurobiology
|

|
25111151 |
Axolotl; Dorsal root ganglia; Neural crest; Neural fold grafting; Size control |
How animals adjust the size of their organs is a fundamental, enduring question in biology. Here we manipulate the amount of neural crest (NC) precursors for the dorsal root ganglia (DRG) in axolotl. We produce embryos with an under- or over-supply of pre-migratory NC in order to find out if DRG can regulate their sizes during development. Axolotl embryos are perfectly suitable for this research. Firstly, they are optimal for microsurgical manipulations and tissue repair. Secondly, they possess, unlike most other vertebrates, only one neural crest string located on top of the neural tube. This condition and position enables NC cells to migrate to either side of the embryo and participate in the regulation of NC cell distribution. We show that size compensation of DRG in axolotl occurs in 2 cm juveniles after undersupply of NC (up-regulation) and in 5 cm juveniles after oversupply of NC (down-regulation). The size of DRG is likely to be regulated locally within the DRG and not via adaptations of the pre-migratory NC or during NC cell migration. Ipsi- and contralateral NC cell migration occurs both in embryos with one and two neural folds, and contralateral migration of NC is the only source for contralateral DRG formation in embryos with only one neural fold. Compensatory size increase is accompanied by an increase in cell division of a DRG precursor pool (PCNA+/SOX2-), rather than by DRG neurons or glial cells. During compensatory size decrease, increased apoptosis and reduced proliferation of DRG cells are observed. |
|
Fischer-Friedrich E, Hyman AA, Jülicher F, Müller DJ, Helenius J
|
Quantification of surface tension and internal pressure generated by single mitotic cells.
|
Sci Rep 2014 Aug 29;4:6213
|
|
Biophysics
|

|
25169063 |
|
During mitosis, adherent cells round up, by increasing the tension of the contractile actomyosin cortex while increasing the internal hydrostatic pressure. In the simple scenario of a liquid cell interior, the surface tension is related to the local curvature and the hydrostatic pressure difference by Laplace's law. However, verification of this scenario for cells requires accurate measurements of cell shape. Here, we use wedged micro-cantilevers to uniaxially confine single cells and determine confinement forces while concurrently determining cell shape using confocal microscopy. We fit experimentally measured confined cell shapes to shapes obeying Laplace's law with uniform surface tension and find quantitative agreement. Geometrical parameters derived from fitting the cell shape, and the measured force were used to calculate hydrostatic pressure excess and surface tension of cells. We find that HeLa cells increase their internal hydrostatic pressure excess and surface tension from ? 40 Pa and 0.2 mNm(-1) during interphase to ? 400 Pa and 1.6 mNm(-1) during metaphase. The method introduced provides a means to determine internal pressure excess and surface tension of rounded cells accurately and with minimal cellular perturbation, and should be applicable to characterize the mechanical properties of various cellular systems. |
|
Santos-Ferreira T, Postel K, Stutzki H, Kurth T, Zeck G, Ader M
|
Daylight vision repair by cell transplantation.
|
Stem Cells 2015 Jan;33(1):79-90
|
|
Cell Biology
|

|
25183393 |
Cone-like photoreceptor; Microelectrode array; Nrl-deficient mouse; Retinal degeneration; Transplantation |
Human daylight vision depends on cone photoreceptors and their degeneration results in visual impairment and blindness as observed in several eye diseases including age-related macular degeneration, cone-rod dystrophies, or late stage retinitis pigmentosa, with no cure available. Preclinical cell replacement approaches in mouse retina have been focusing on rod dystrophies, due to the availability of sufficient donor material from the rod-dominated mouse retina, leaving the development of treatment options for cone degenerations not well studied. Thus, an abundant and traceable source for donor cone-like photoreceptors was generated by crossing neural retina leucine zipper-deficient (Nrl(-/-) ) mice with an ubiquitous green fluorescent protein (GFP) reporter line resulting in double transgenic tg(Nrl(-/-); aGFP) mice. In Nrl(-/-) retinas, all rods are converted into cone-like photoreceptors that express CD73 allowing their enrichment by CD73-based magnetic activated cell sorting prior transplantation into the subretinal space of adult wild-type, cone-only (Nrl(-/-)), or cone photoreceptor function loss 1 (Cpfl1) mice. Donor cells correctly integrated into host retinas, acquired mature photoreceptor morphology, expressed cone-specific markers, and survived for up to 6 months, with significantly increased integration rates in the cone-only Nrl(-/-) retina. Individual retinal ganglion cell recordings demonstrated the restoration of photopic responses in cone degeneration mice following transplantation suggesting, for the first time, the feasibility of daylight vision repair by cell replacement in the adult mammalian retina. |
|
Kizil C, Küchler B, Yan JJ, Özhan G, Moro E, Argenton F, Brand M, Weidinger G, Antos CL
|
Simplet/Fam53b is required for Wnt signal transduction by regulating β-catenin nuclear localization.
|
Development 2014 Sep;141(18):3529-39
|
|
Cell Biology
|

|
25183871 |
Embryogenesis; Nuclear localization; Simplet/Fam53b; Wnt signaling; Zebrafish; β-Catenin |
Canonical β-catenin-dependent Wnt signal transduction is important for several biological phenomena, such as cell fate determination, cell proliferation, stem cell maintenance and anterior-posterior axis formation. The hallmark of canonical Wnt signaling is the translocation of β-catenin into the nucleus where it activates gene transcription. However, the mechanisms regulating β-catenin nuclear localization are poorly understood. We show that Simplet/Fam53B (Smp) is required for Wnt signaling by positively regulating β-catenin nuclear localization. In the zebrafish embryo, the loss of smp blocks the activity of two β-catenin-dependent reporters and the expression of Wnt target genes, and prevents nuclear accumulation of β-catenin. Conversely, overexpression of smp increases β-catenin nuclear localization and transcriptional activity in vitro and in vivo. Expression of mutant Smp proteins lacking either the nuclear localization signal or the β-catenin interaction domain reveal that the translocation of Smp into the nucleus is essential for β-catenin nuclear localization and Wnt signaling in vivo. We also provide evidence that mammalian Smp is involved in regulating β-catenin nuclear localization: the protein colocalizes with β-catenin-dependent gene expression in mouse intestinal crypts; siRNA knockdown of Smp reduces β-catenin nuclear localization and transcriptional activity; human SMP mediates β-catenin transcriptional activity in a dose-dependent manner; and the human SMP protein interacts with human β-catenin primarily in the nucleus. Thus, our findings identify the evolutionary conserved SMP protein as a regulator of β-catenin-dependent Wnt signal transduction. |
|
Merkel M, Sagner A, Gruber FS, Etournay R, Blasse C, Myers E, Eaton S, Jülicher F
|
The balance of prickle/spiny-legs isoforms controls the amount of coupling between core and fat PCP systems.
|
Curr. Biol. 2014 Sep 22;24(18):2111-23
|
|
Developmental Biology
|

|
25201685 |
|
The conserved Fat and Core planar cell polarity (PCP) pathways work together to specify tissue-wide orientation of hairs and ridges in the Drosophila wing. Their components form intracellularly polarized complexes at adherens junctions that couple the polarity of adjacent cells and form global patterns. How Fat and Core PCP systems interact is not understood. Some studies suggest that Fat PCP directly orients patterns formed by Core PCP components. Others implicate oriented tissue remodeling in specifying Core PCP patterns. |
|
Fei JF, Schuez M, Tazaki A, Taniguchi Y, Roensch K, Tanaka EM
|
CRISPR-mediated genomic deletion of Sox2 in the axolotl shows a requirement in spinal cord neural stem cell amplification during tail regeneration.
|
Stem Cell Reports 2014 Sep 9;3(3):444-59
|
|
Cell Biology
|

|
25241743 |
|
The salamander is the only tetrapod that functionally regenerates all cell types of the limb and spinal cord (SC) and thus represents an important regeneration model, but the lack of gene-knockout technology has limited molecular analysis. We compared transcriptional activator-like effector nucleases (TALENs) and clustered regularly interspaced short palindromic repeats (CRISPRs) in the knockout of three loci in the axolotl and find that CRISPRs show highly penetrant knockout with less toxic effects compared to TALENs. Deletion of Sox2 in up to 100% of cells yielded viable F0 larvae with normal SC organization and ependymoglial cell marker expression such as GFAP and ZO-1. However, upon tail amputation, neural stem cell proliferation was inhibited, resulting in spinal-cord-specific regeneration failure. In contrast, the mesodermal blastema formed normally. Sox3 expression during development, but not regeneration, most likely allowed embryonic survival and the regeneration-specific phenotype. This analysis represents the first tissue-specific regeneration phenotype from the genomic deletion of a gene in the axolotl. |
|
Millonigg S, Minasaki R, Nousch M, Novak J, Eckmann CR
|
GLD-4-mediated translational activation regulates the size of the proliferative germ cell pool in the adult C. elegans germ line.
|
PLoS Genet. 2014 Sep 25;10(9):e1004647
|
|
Cell Biology
|

|
25254367 |
|
To avoid organ dysfunction as a consequence of tissue diminution or tumorous growth, a tight balance between cell proliferation and differentiation is maintained in metazoans. However, cell-intrinsic gene expression mechanisms controlling adult tissue homeostasis remain poorly understood. By focusing on the adult Caenorhabditis elegans reproductive tissue, we show that translational activation of mRNAs is a fundamental mechanism to maintain tissue homeostasis. Our genetic experiments identified the Trf4/5-type cytoplasmic poly(A) polymerase (cytoPAP) GLD-4 and its enzymatic activator GLS-1 to perform a dual role in regulating the size of the proliferative zone. Consistent with a ubiquitous expression of GLD-4 cytoPAP in proliferative germ cells, its genetic activity is required to maintain a robust proliferative adult germ cell pool, presumably by regulating many mRNA targets encoding proliferation-promoting factors. Based on translational reporters and endogenous protein expression analyses, we found that gld-4 activity promotes GLP-1/Notch receptor expression, an essential factor of continued germ cell proliferation. RNA-protein interaction assays documented also a physical association of the GLD-4/GLS-1 cytoPAP complex with glp-1 mRNA, and ribosomal fractionation studies established that GLD-4 cytoPAP activity facilitates translational efficiency of glp-1 mRNA. Moreover, we found that in proliferative cells the differentiation-promoting factor, GLD-2 cytoPAP, is translationally repressed by the stem cell factor and PUF-type RNA-binding protein, FBF. This suggests that cytoPAP-mediated translational activation of proliferation-promoting factors, paired with PUF-mediated translational repression of differentiation factors, forms a translational control circuit that expands the proliferative germ cell pool. Our additional genetic experiments uncovered that the GLD-4/GLS-1 cytoPAP complex promotes also differentiation, forming a redundant translational circuit with GLD-2 cytoPAP and the translational repressor GLD-1 to restrict proliferation. Together with previous findings, our combined data reveals two interconnected translational activation/repression circuitries of broadly conserved RNA regulators that maintain the balance between adult germ cell proliferation and differentiation. |
|
Perini ED, Schaefer R, Stöter M, Kalaidzidis Y, Zerial M
|
Mammalian CORVET is required for fusion and conversion of distinct early endosome subpopulations.
|
Traffic 2014 Dec 06;15(12):1366-89
|
|
Cell Biology
|

|
25266290 |
APPL1; CORVET; EEA1; HOPS; early endosomes; endocytosis; tethering factor |
Early endosomes are organized in a network of vesicles shaped by cycles of fusion, fission, and conversion to late endosomes. In yeast, endosome fusion and conversion are regulated, among others, by CORVET, a hexameric protein complex. In the mammalian endocytic system, distinct subpopulations of early endosomes labelled by the Rab5 effectors APPL1 and EEA1 are present. Here, the function of mammalian CORVET with respect to these endosomal subpopulations was investigated. Tgfbrap1 as CORVET-specific subunit and functional ortholog of Vps3p was identified, demonstrating that it is differentially distributed between APPL1 and EEA1 endosomes. Surprisingly, depletion of CORVET-specific subunits caused fragmentation of APPL1-positive endosomes but not EEA1 endosomes in vivo. These and in vitro data suggest that CORVET plays a role in endosome fusion independently of EEA1. Depletion of CORVET subunits caused accumulation of large EEA1 endosomes indicative of another role in the conversion of EEA1 endosomes into late endosomes. In addition, depletion of CORVET-specific subunits caused alterations in transport depending on both the type of cargo and the specific endosomal subpopulation. These results demonstrate that CORVET plays distinct roles at multiple stages in the mammalian endocytic pathway. |
|
Zieske K, Schwille P
|
Reconstitution of self-organizing protein gradients as spatial cues in cell-free systems.
|
Elife 2014 Oct 01;3
|
|
Biophysics
|

|
25271375 |
E. coli; FtsZ; biophysics; cell biology; cell division; cell-free reconstitution; cytoskeleton; min proteins; protein gradient; structural biology |
Intracellular protein gradients are significant determinants of spatial organization. However, little is known about how protein patterns are established, and how their positional information directs downstream processes. We have accomplished the reconstitution of a protein concentration gradient that directs the assembly of the cell division machinery in E.coli from the bottom-up. Reconstituting self-organized oscillations of MinCDE proteins in membrane-clad soft-polymer compartments, we demonstrate that distinct time-averaged protein concentration gradients are established. Our minimal system allows to study complex organizational principles, such as spatial control of division site placement by intracellular protein gradients, under simplified conditions. In particular, we demonstrate that FtsZ, which marks the cell division site in many bacteria, can be targeted to the middle of a cell-like compartment. Moreover, we show that compartment geometry plays a major role in Min gradient establishment, and provide evidence for a geometry-mediated mechanism to partition Min proteins during bacterial development. |
|
Brankatschk M, Dunst S, Nemetschke L, Eaton S
|
Delivery of circulating lipoproteins to specific neurons in the Drosophila brain regulates systemic insulin signaling.
|
Elife 2014 Oct 02;3
|
|
Cell Biology
|

|
25275323 |
D. melanogaster; blood brain barrier; developmental biology; insulin; lipoprotein; neuroscience; stem cells |
The Insulin signaling pathway couples growth, development and lifespan to nutritional conditions. Here, we demonstrate a function for the Drosophila lipoprotein LTP in conveying information about dietary lipid composition to the brain to regulate Insulin signaling. When yeast lipids are present in the diet, free calcium levels rise in Blood Brain Barrier glial cells. This induces transport of LTP across the Blood Brain Barrier by two LDL receptor-related proteins: LRP1 and Megalin. LTP accumulates on specific neurons that connect to cells that produce Insulin-like peptides, and induces their release into the circulation. This increases systemic Insulin signaling and the rate of larval development on yeast-containing food compared with a plant-based food of similar nutritional content. |
|
Anitei M, Chenna R, Czupalla C, Esner M, Christ S, Lenhard S, Korn K, Meyenhofer F, Bickle M, Zerial M, Hoflack B
|
A high-throughput siRNA screen identifies genes that regulate mannose 6-phosphate receptor trafficking.
|
J. Cell. Sci. 2014 Dec 1;127(Pt 23):5079-92
|
|
Cell Biology
|

|
25278553 |
Lysosome; Mannose 6-phosphate receptor; Post-Golgi transport; Trafficking; siRNA screen |
The delivery of newly synthesized soluble lysosomal hydrolases to the endosomal system is essential for lysosome function and cell homeostasis. This process relies on the proper trafficking of the mannose 6-phosphate receptors (MPRs) between the trans-Golgi network (TGN), endosomes and the plasma membrane. Many transmembrane proteins regulating diverse biological processes ranging from virus production to the development of multicellular organisms also use these pathways. To explore how cell signaling modulates MPR trafficking, we used high-throughput RNA interference (RNAi) to target the human kinome and phosphatome. Using high-content image analysis, we identified 127 kinases and phosphatases belonging to different signaling networks that regulate MPR trafficking and/or the dynamic states of the subcellular compartments encountered by the MPRs. Our analysis maps the MPR trafficking pathways based on enzymes regulating phosphatidylinositol phosphate metabolism. Furthermore, it reveals how cell signaling controls the biogenesis of post-Golgi tubular carriers destined to enter the endosomal system through a SRC-dependent pathway regulating ARF1 and RAC1 signaling and myosin II activity. |
|
Gibson KH, Vorkel D, Meissner J, Verbavatz JM
|
Fluorescing the electron: strategies in correlative experimental design.
|
Methods Cell Biol. 2014;124:23-54
|
|
Imaging Technologies Development
|

|
25287835 |
Correlative microscopy; Electron microscopy; Electron tomography; Fluorescence microscopy; Green fluorescent protein (GFP); High pressure freezing; Image registration; Live cell imaging |
Correlative light and electron microscopy (CLEM) encompasses a growing number of imaging techniques aiming to combine the benefits of light microscopy, which allows routine labeling of molecules and live-cell imaging of fluorescently tagged proteins with the resolution and ultrastructural detail provided by electron microscopy (EM). Here we review three different strategies that are commonly used in CLEM and we illustrate each approach with one detailed example of their application. The focus is on different options for sample preparation with their respective benefits as well as on the imaging workflows that can be used. The three strategies cover: (1) the combination of live-cell imaging with the high resolution of EM (time-resolved CLEM), (2) the need to identify a fluorescent cell of interest for further exploration by EM (cell sorting), and (3) the subcellular correlation of a fluorescent feature in a cell with its associated ultrastructural features (spatial CLEM). Finally, we discuss future directions for CLEM exploring the possibilities for combining super-resolution microscopy with EM. |
|
Tsurkan MV, Wetzel R, Pérez-Hernández HR, Chwalek K, Kozlova A, Freudenberg U, Kempermann G, Zhang Y, Lasagni AF, Werner C
|
Photopatterning of multifunctional hydrogels to direct adult neural precursor cells.
|
Adv Healthc Mater 2015 Mar 11;4(4):516-21
|
|
Cell Biology
|
|
25323149 |
biohybrid hydrogels; multilayer surfaces; neural precursor cells; photocleavable soft matter; photopatterning |
Matrix-metalloproteinase and photosensitive peptide units are combined with heparin and poly(ethylene glycol) into a light-sensitive multicomponent hydrogel material. Localized degradation of the hydrogel matrix allows the creation of defined spatial constraints and adhesive patterning for cells grown in culture. Using this matrix system, it is demonstrated that the degree of confinement determines the fate of neural precursor cells in vitro. |
|
Masjkur J, Arps-Forker C, Poser SW, Nikolakopoulou P, Toutouna L, Chenna R, Chavakis T, Chatzigeorgiou A, Chen LS, Dubrovska A, Choudhary P, Uphues I, Mark M, Bornstein SR, Androutsellis-Theotokis A
|
Hes3 is expressed in the adult pancreatic islet and regulates gene expression, cell growth, and insulin release.
|
J. Biol. Chem. 2014 Dec 19;289(51):35503-16
|
|
Medical Biology
|

|
25371201 |
Beta Cell (B-cell); Cell Culture; Islet; Neural Stem Cell (NSC); Neurodegenerative Disease; Neuroprogenitor Cell; Notch Pathway; Pancreas; Parkinson Disease; Signal Transduction |
The transcription factor Hes3 is a component of a signaling pathway that supports the growth of neural stem cells with profound consequences in neurodegenerative disease models. Here we explored whether Hes3 also regulates pancreatic islet cells. We showed that Hes3 is expressed in human and rodent pancreatic islets. In mouse islets it co-localizes with alpha and beta cell markers. We employed the mouse insulinoma cell line MIN6 to perform in vitro characterization and functional studies in conditions known to modulate Hes3 based upon our previous work using neural stem cell cultures. In these conditions, cells showed elevated Hes3 expression and nuclear localization, grew efficiently, and showed higher evoked insulin release responses, compared with serum-containing conditions. They also exhibited higher expression of the transcription factor Pdx1 and insulin. Furthermore, they were responsive to pharmacological treatments with the GLP-1 analog Exendin-4, which increased nuclear Hes3 localization. We employed a transfection approach to address specific functions of Hes3. Hes3 RNA interference opposed cell growth and affected gene expression as revealed by DNA microarrays. Western blotting and PCR approaches specifically showed that Hes3 RNA interference opposes the expression of Pdx1 and insulin. Hes3 overexpression (using a Hes3-GFP fusion construct) confirmed a role of Hes3 in regulating Pdx1 expression. Hes3 RNA interference reduced evoked insulin release. Mice lacking Hes3 exhibited increased islet damage by streptozotocin. These data suggest roles of Hes3 in pancreatic islet function. |
|
Traikov S, Stange C, Wassmer T, Paul-Gilloteaux P, Salamero J, Raposo G, Hoflack B
|
Septin6 and Septin7 GTP binding proteins regulate AP-3- and ESCRT-dependent multivesicular body biogenesis.
|
PLoS ONE 2014 Nov 07;9(11):e109372
|
- EMF & Histo CMCB
- LMF CMCB
|
Cell Biology
|

|
25380047 |
|
Septins (SEPTs) form a family of GTP-binding proteins implicated in cytoskeleton and membrane organization, cell division and host/pathogen interactions. The precise function of many family members remains elusive. We show that SEPT6 and SEPT7 complexes bound to F-actin regulate protein sorting during multivesicular body (MVB) biogenesis. These complexes bind AP-3, an adapter complex sorting cargos destined to remain in outer membranes of maturing endosomes, modulate AP-3 membrane interactions and the motility of AP-3-positive endosomes. These SEPT-AP interactions also influence the membrane interaction of ESCRT (endosomal-sorting complex required for transport)-I, which selects ubiquitinated cargos for degradation inside MVBs. Whereas our findings demonstrate that SEPT6 and SEPT7 function in the spatial, temporal organization of AP-3- and ESCRT-coated membrane domains, they uncover an unsuspected coordination of these sorting machineries during MVB biogenesis. This requires the E3 ubiquitin ligase LRSAM1, an AP-3 interactor regulating ESCRT-I sorting activity and whose mutations are linked with Charcot-Marie-Tooth neuropathies. |
|
Guarino E, Cojoc G, García-Ulloa A, Tolić IM, Kearsey SE
|
Real-time imaging of DNA damage in yeast cells using ultra-short near-infrared pulsed laser irradiation.
|
PLoS ONE 2014 Nov 19;9(11):e113325
|
|
Imaging Technologies Development
|
|
25409521 |
|
Analysis of accumulation of repair and checkpoint proteins at repair sites in yeast nuclei has conventionally used chemical agents, ionizing radiation or induction of endonucleases to inflict localized damage. In addition to these methods, similar studies in mammalian cells have used laser irradiation, which has the advantage that damage is inflicted at a specific nuclear region and at a precise time, and this allows accurate kinetic analysis of protein accumulation at DNA damage sites. We show here that it is feasible to use short pulses of near-infrared laser irradiation to inflict DNA damage in subnuclear regions of yeast nuclei by multiphoton absorption. In conjunction with use of fluorescently-tagged proteins, this allows quantitative analysis of protein accumulation at damage sites within seconds of damage induction. PCNA accumulated at damage sites rapidly, such that maximum accumulation was seen approximately 50 s after damage, then levels declined linearly over 200-1000 s after irradiation. RPA accumulated with slower kinetics such that hardly any accumulation was detected within 60 s of irradiation, and levels subsequently increased linearly over the next 900 s, after which levels were approximately constant (up to ca. 2700 s) at the damage site. This approach complements existing methodologies to allow analysis of key damage sensors and chromatin modification changes occurring within seconds of damage inception. |
|
Weber B, Tranfield EM, Höög JL, Baum D, Antony C, Hyman T, Verbavatz JM, Prohaska S
|
Automated stitching of microtubule centerlines across serial electron tomograms.
|
PLoS ONE 2014 Dec 01;9(12):e113222
|
|
Image Processing
|

|
25438148 |
|
Tracing microtubule centerlines in serial section electron tomography requires microtubules to be stitched across sections, that is lines from different sections need to be aligned, endpoints need to be matched at section boundaries to establish a correspondence between neighboring sections, and corresponding lines need to be connected across multiple sections. We present computational methods for these tasks: 1) An initial alignment is computed using a distance compatibility graph. 2) A fine alignment is then computed with a probabilistic variant of the iterative closest points algorithm, which we extended to handle the orientation of lines by introducing a periodic random variable to the probabilistic formulation. 3) Endpoint correspondence is established by formulating a matching problem in terms of a Markov random field and computing the best matching with belief propagation. Belief propagation is not generally guaranteed to converge to a minimum. We show how convergence can be achieved, nonetheless, with minimal manual input. In addition to stitching microtubule centerlines, the correspondence is also applied to transform and merge the electron tomograms. We applied the proposed methods to samples from the mitotic spindle in C. elegans, the meiotic spindle in X. laevis, and sub-pellicular microtubule arrays in T. brucei. The methods were able to stitch microtubules across section boundaries in good agreement with experts' opinions for the spindle samples. Results, however, were not satisfactory for the microtubule arrays. For certain experiments, such as an analysis of the spindle, the proposed methods can replace manual expert tracing and thus enable the analysis of microtubules over long distances with reasonable manual effort. |
|
Rodenfels J, Lavrynenko O, Ayciriex S, Sampaio JL, Carvalho M, Shevchenko A, Eaton S
|
Production of systemically circulating Hedgehog by the intestine couples nutrition to growth and development.
|
Genes Dev. 2014 Dec 1;28(23):2636-51
|
|
Cell Biology
|

|
25452274 |
Drosophila; Hedgehog; growth; lipid metabolism; steroid hormones |
In Drosophila larvae, growth and developmental timing are regulated by nutrition in a tightly coordinated fashion. The networks that couple these processes are far from understood. Here, we show that the intestine responds to nutrient availability by regulating production of a circulating lipoprotein-associated form of the signaling protein Hedgehog (Hh). Levels of circulating Hh tune the rates of growth and developmental timing in a coordinated fashion. Circulating Hh signals to the fat body to control larval growth. It regulates developmental timing by controlling ecdysteroid production in the prothoracic gland. Circulating Hh is especially important during starvation, when it is also required for mobilization of fat body triacylglycerol (TAG) stores. Thus, we demonstrate that Hh, previously known only for its local morphogenetic functions, also acts as a lipoprotein-associated endocrine hormone, coordinating the response of multiple tissues to nutrient availability. |
|
Meinhardt A, Eberle D, Tazaki A, Ranga A, Niesche M, Wilsch-Bräuninger M, Stec A, Schackert G, Lutolf M, Tanaka EM
|
3D reconstitution of the patterned neural tube from embryonic stem cells.
|
Stem Cell Reports 2014 Dec 9;3(6):987-99
|
|
Cell Biology
|

|
25454634 |
|
Inducing organogenesis in 3D culture is an important aspect of stem cell research. Anterior neural structures have been produced from large embryonic stem cell (ESC) aggregates, but the steps involved in patterning such complex structures have been ill defined, as embryoid bodies typically contained many cell types. Here we show that single mouse ESCs directly embedded in Matrigel or defined synthetic matrices under neural induction conditions can clonally form neuroepithelial cysts containing a single lumen in 3D. Untreated cysts were uniformly dorsal and could be ventralized to floor plate (FP). Retinoic acid posteriorized cysts to cervical levels and induced localize FP formation yielding full patterning along the dorsal/ventral (DV) axis. Correct spatial organization of motor neurons, interneurons, and dorsal interneurons along the DV axis was observed. This system serves as a valuable tool for studying morphogen action in 3D and as a source of patterned spinal cord tissue. |
|
Gandhi H, Worch R, Kurgonaite K, Hintersteiner M, Schwille P, Bökel C, Weidemann T
|
Dynamics and interaction of interleukin-4 receptor subunits in living cells.
|
Biophys. J. 2014 Dec 2;107(11):2515-27
|
|
Cell Biology
|

|
25468331 |
|
It has long been established that dimerization of Interleukin-4 receptor (IL-4R) subunits is a pivotal step for JAK/STAT signal transduction. However, ligand-induced complex formation at the surface of living cells has been challenging to observe. Here we report an experimental assay employing trisNTA dyes for orthogonal, external labeling of eGFP-tagged receptor constructs that allows the quantification of receptor heterodimerization by dual-color fluorescence cross-correlation spectroscopy. Fluorescence cross-correlation spectroscopy analysis at the plasma membrane shows that IL-4R subunit dimerization is indeed a strictly ligand-induced process. Under conditions of saturating cytokine occupancy, we determined intramembrane dissociation constants (K(d,2D)) of 180 and 480 receptors per ?m(2) for the type-2 complexes IL-4:IL-4R?/IL-13R?1 and IL-13:IL-13R?1/IL-4R?, respectively. For the lower affinity type-1 complex IL-4:IL-4R?/IL-2R?, we estimated a K(d,2D) of ?1000 receptors per ?m(2). The receptor densities required for effective dimerization thus exceed the typical, average expression levels by several orders of magnitude. In addition, we find that all three receptor subunits accumulate rapidly within a subpopulation of early sorting and recycling endosomes stably anchored just beneath the plasma membrane (cortical endosomes, CEs). The receptors, as well as labeled IL-4 and trisNTA ligands are specifically trafficked into CEs by a constitutive internalization mechanism. This may compensate for the inherent weak affinities that govern ligand-induced receptor dimerization at the plasma membrane. Consistently, activated receptors are also concentrated at the CEs. Our observations thus suggest that receptor trafficking may play an important role for the regulation of IL-4R-mediated JAK/STAT signaling. |
|
Umetsu D, Dunst S, Dahmann C
|
An RNA interference screen for genes required to shape the anteroposterior compartment boundary in Drosophila identifies the Eph receptor.
|
PLoS ONE 2014 Dec 04;9(12):e114340
|
|
Developmental Biology
|

|
25473846 |
|
The formation of straight compartment boundaries separating groups of cells with distinct fates and functions is an evolutionarily conserved strategy during animal development. The physical mechanisms that shape compartment boundaries have recently been further elucidated, however, the molecular mechanisms that underlie compartment boundary formation and maintenance remain poorly understood. Here, we report on the outcome of an RNA interference screen aimed at identifying novel genes involved in maintaining the straight shape of the anteroposterior compartment boundary in Drosophila wing imaginal discs. Out of screening 3114 transgenic RNA interference lines targeting a total of 2863 genes, we identified a single novel candidate that interfered with the formation of a straight anteroposterior compartment boundary. Interestingly, the targeted gene encodes for the Eph receptor tyrosine kinase, an evolutionarily conserved family of signal transducers that has previously been shown to be important for maintaining straight compartment boundaries in vertebrate embryos. Our results identify a hitherto unknown role of the Eph receptor tyrosine kinase in Drosophila and suggest that Eph receptors have important functions in shaping compartment boundaries in both vertebrate and insect development. |
|
Özlü N, Qureshi MH, Toyoda Y, Renard BY, Mollaoglu G, Özkan NE, Bulbul S, Poser I, Timm W, Hyman AA, Mitchison TJ, Steen JA
|
Quantitative comparison of a human cancer cell surface proteome between interphase and mitosis.
|
EMBO J. 2015 Jan 13;34(2):251-65
|
|
Cell Biology
|

|
25476450 |
PCDH7; SILAC; cell cycle; cell rounding; cell surface |
The cell surface is the cellular compartment responsible for communication with the environment. The interior of mammalian cells undergoes dramatic reorganization when cells enter mitosis. These changes are triggered by activation of the CDK1 kinase and have been studied extensively. In contrast, very little is known of the cell surface changes during cell division. We undertook a quantitative proteomic comparison of cell surface-exposed proteins in human cancer cells that were tightly synchronized in mitosis or interphase. Six hundred and twenty-eight surface and surface-associated proteins in HeLa cells were identified; of these, 27 were significantly enriched at the cell surface in mitosis and 37 in interphase. Using imaging techniques, we confirmed the mitosis-selective cell surface localization of protocadherin PCDH7, a member of a family with anti-adhesive roles in embryos. We show that PCDH7 is required for development of full mitotic rounding pressure at the onset of mitosis. Our analysis provided basic information on how cell cycle progression affects the cell surface. It also provides potential pharmacodynamic biomarkers for anti-mitotic cancer chemotherapy. |
|
Günther C, Kind B, Reijns MA, Berndt N, Martinez-Bueno M, Wolf C, Tüngler V, Chara O, Lee YA, Hübner N, Bicknell L, Blum S, Krug C, Schmidt F, Kretschmer S, Koss S, Astell KR, Ramantani G, Bauerfeind A, Morris DL, Cunninghame Graham DS, Bubeck D, Leitch A, Ralston SH, Blackburn EA, Gahr M, Witte T, Vyse TJ, Melchers I, Mangold E, Nöthen MM, Aringer M, Kuhn A, Lüthke K, Unger L, Bley A, Lorenzi A, Isaacs JD, Alexopoulou D, Conrad K, Dahl A, Roers A, Alarcon-Riquelme ME, Jackson AP, Lee-Kirsch MA
|
Defective removal of ribonucleotides from DNA promotes systemic autoimmunity.
|
J. Clin. Invest. 2015 Jan 15;125(1):413-24
|
|
Medical Biology
|

|
25500883 |
|
Genome integrity is continuously challenged by the DNA damage that arises during normal cell metabolism. Biallelic mutations in the genes encoding the genome surveillance enzyme ribonuclease H2 (RNase H2) cause Aicardi-Goutières syndrome (AGS), a pediatric disorder that shares features with the autoimmune disease systemic lupus erythematosus (SLE). Here we determined that heterozygous parents of AGS patients exhibit an intermediate autoimmune phenotype and demonstrated a genetic association between rare RNASEH2 sequence variants and SLE. Evaluation of patient cells revealed that SLE- and AGS-associated mutations impair RNase H2 function and result in accumulation of ribonucleotides in genomic DNA. The ensuing chronic low level of DNA damage triggered a DNA damage response characterized by constitutive p53 phosphorylation and senescence. Patient fibroblasts exhibited constitutive upregulation of IFN-stimulated genes and an enhanced type I IFN response to the immunostimulatory nucleic acid polyinosinic:polycytidylic acid and UV light irradiation, linking RNase H2 deficiency to potentiation of innate immune signaling. Moreover, UV-induced cyclobutane pyrimidine dimer formation was markedly enhanced in ribonucleotide-containing DNA, providing a mechanism for photosensitivity in RNase H2-associated SLE. Collectively, our findings implicate RNase H2 in the pathogenesis of SLE and suggest a role of DNA damage-associated pathways in the initiation of autoimmunity. |
|
Naganathan SR, Fürthauer S, Nishikawa M, Jülicher F, Grill SW
|
Active torque generation by the actomyosin cell cortex drives left-right symmetry breaking.
|
Elife 2014 Dec 17;3:e04165
|
|
Biophysics
|

|
25517077 |
C. elegans; L/R symmetry breaking; Wnt signaling; active torques; actomyosin cortex; biophysics; hydrodynamics; structural biology |
Many developmental processes break left-right (LR) symmetry with a consistent handedness. LR asymmetry emerges early in development, and in many species the primary determinant of this asymmetry has been linked to the cytoskeleton. However, the nature of the underlying chirally asymmetric cytoskeletal processes has remained elusive. In this study, we combine thin-film active chiral fluid theory with experimental analysis of the C. elegans embryo to show that the actomyosin cortex generates active chiral torques to facilitate chiral symmetry breaking. Active torques drive chiral counter-rotating cortical flow in the zygote, depend on myosin activity, and can be altered through mild changes in Rho signaling. Notably, they also execute the chiral skew event at the 4-cell stage to establish the C. elegans LR body axis. Taken together, our results uncover a novel, large-scale physical activity of the actomyosin cytoskeleton that provides a fundamental mechanism for chiral morphogenesis in development. |
|
Artegiani B, de Jesus Domingues AM, Bragado Alonso S, Brandl E, Massalini S, Dahl A, Calegari F
|
Tox: a multifunctional transcription factor and novel regulator of mammalian corticogenesis.
|
EMBO J. 2015 Apr 1;34(7):896-910
|
- EMF & Histo CMCB
- LMF CMCB
|
Developmental Biology
|

|
25527292 |
DamID sequencing; HMG?box transcription factors; Tox; brain development; neural stem cells |
Major efforts are invested to characterize the factors controlling the proliferation of neural stem cells. During mammalian corticogenesis, our group has identified a small pool of genes that are transiently downregulated in the switch of neural stem cells to neurogenic division and reinduced in newborn neurons. Among these switch genes, we found Tox, a transcription factor with hitherto uncharacterized roles in the nervous system. Here, we investigated the role of Tox in corticogenesis by characterizing its expression at the tissue, cellular and temporal level. We found that Tox is regulated by calcineurin/Nfat signalling. Moreover, we combined DNA adenine methyltransferase identification (DamID) with deep sequencing to characterize the chromatin binding properties of Tox including its motif and downstream transcriptional targets including Sox2, Tbr2, Prox1 and other key factors. Finally, we manipulated Tox in the developing brain and validated its multiple roles in promoting neural stem cell proliferation and neurite outgrowth of newborn neurons. Our data provide a valuable resource to study the role of Tox in other tissues and highlight a novel key player in brain development. |
|
Reynaud EG, Peychl J, Huisken J, Tomancak P
|
Guide to light-sheet microscopy for adventurous biologists.
|
Nat. Methods 2015 Jan;12(1):30-4
|
|
Imaging Technologies Development
|

|
25549268 |
|
|
|
Ehret F, Vogler S, Pojar S, Elliott DA, Bradke F, Steiner B, Kempermann G
|
Mouse model of CADASIL reveals novel insights into Notch3 function in adult hippocampal neurogenesis.
|
Neurobiol. Dis. 2015 Mar 31;75:131-41
|
- EMF & Histo CMCB
- LMF DZNE
|
Neurobiology
|

|
25555543 |
Adult neurogenesis; CADASIL; Notch3; Stem cell |
Could impaired adult hippocampal neurogenesis be a relevant mechanism underlying CADASIL (cerebral autosomal dominant arteriopathy with subcortical infarcts and leukoencephalopathy)? Memory symptoms in CADASIL, the most common hereditary form of vascular dementia, are usually thought to be primarily due to vascular degeneration and white matter lacunes. Since adult hippocampal neurogenesis, a process essential for the integration of new spatial memory occurs in a highly vascularized niche, we considered dysregulation of adult neurogenesis as a potential mechanism for the manifestation of dementia in CADASIL. Analysis in aged mice overexpressing Notch3 with a CADASIL mutation, revealed vascular deficits in arteries of the hippocampal fissure but not in the niche of the dentate gyrus. At 12 months of age, cell proliferation and survival of newborn neurons were reduced not only in CADASIL mice but also in transgenic controls overexpressing wild type Notch3. At 6 months, hippocampal neurogenesis was altered in CADASIL mice independent of overt vascular abnormalities in the fissure. Further, we identified Notch3 expression in hippocampal precursor cells and maturing neurons in vivo as well as in cultured hippocampal precursor cells. Overexpression and knockdown experiments showed that Notch3 signaling negatively regulated precursor cell proliferation. Notch3 overexpression also led to deficits in KCl-induced precursor cell activation. This suggests a cell-autonomous effect of Notch3 signaling in the regulation of precursor proliferation and activation and a loss-of-function effect in CADASIL. Consequently, besides vascular damage, aberrant precursor cell proliferation and differentiation due to Notch3 dysfunction might be an additional independent mechanism for the development of hippocampal dysfunction in CADASIL. |
|
Torkko JM, Primo ME, Dirkx R, Friedrich A, Viehrig A, Vergari E, Borgonovo B, Sönmez A, Wegbrod C, Lachnit M, Münster C, Sica MP, Ermácora MR, Solimena M
|
Stability of proICA512/IA-2 and its targeting to insulin secretory granules require β4-sheet-mediated dimerization of its ectodomain in the endoplasmic reticulum.
|
Mol. Cell. Biol. 2015 Mar 05;35(6):914-27
|
|
Cell Biology
|

|
25561468 |
|
The type 1 diabetes autoantigen ICA512/IA-2/RPTPN is a receptor protein tyrosine phosphatase of the insulin secretory granules (SGs) which regulates the size of granule stores, possibly via cleavage/signaling of its cytosolic tail. The role of its extracellular region remains unknown. Structural studies indicated that β2- or β4-strands in the mature ectodomain (ME ICA512) form dimers in vitro. Here we show that ME ICA512 prompts proICA512 dimerization in the endoplasmic reticulum. Perturbation of ME ICA512 β2-strand N-glycosylation upon S508A replacement allows for proICA512 dimerization, O-glycosylation, targeting to granules, and conversion, which are instead precluded upon G553D replacement in the ME ICA512 β4-strand. S508A/G553D and N506A/G553D double mutants dimerize but remain in the endoplasmic reticulum. Removal of the N-terminal fragment (ICA512-NTF) preceding ME ICA512 allows an ICA512-ΔNTF G553D mutant to exit the endoplasmic reticulum, and ICA512-ΔNTF is constitutively delivered to the cell surface. The signal for SG sorting is located within the NTF RESP18 homology domain (RESP18-HD), whereas soluble NTF is retained in the endoplasmic reticulum. Hence, we propose that the ME ICA512 β2-strand fosters proICA512 dimerization until NTF prevents N506 glycosylation. Removal of this constraint allows for proICA512 β4-strand-induced dimerization, exit from the endoplasmic reticulum, O-glycosylation, and RESP18-HD-mediated targeting to granules. |
|
Strzyz PJ, Lee HO, Sidhaye J, Weber IP, Leung LC, Norden C
|
Interkinetic nuclear migration is centrosome independent and ensures apical cell division to maintain tissue integrity.
|
Dev. Cell 2015 Jan 26;32(2):203-19
|
|
Cell Biology
|

|
25600237 |
|
Pseudostratified epithelia are widespread during animal development and feature elongated cells whose nuclei adopt various positions along the apicobasal cell axis. Before mitosis, nuclei migrate toward the apical surface, and subsequent divisions occur apically. So far, the exact purpose of this nuclear migration remained elusive. One hypothesis was that apical migration ensures that nuclei and centrosomes meet for mitosis. We here demonstrate that in zebrafish neuroepithelia apical nuclear migration occurs independently of centrosome position or integrity. It is a highly reproducible phenomenon linked to the cell cycle via CDK1 activity. We propose that the robustness of bringing nuclei apically for mitosis ensures that cells are capable of reintegrating into the epithelium after division. Nonapical divisions lead to cell delamination and formation of cell clusters that subsequently interfere with neuronal layering. Therefore, positioning divisions apically in pseudostratified neuroepithelia could serve to safeguard epithelial integrity and enable proper proliferation and maturation. |
|
Hoboth P, Müller A, Ivanova A, Mziaut H, Dehghany J, Sönmez A, Lachnit M, Meyer-Hermann M, Kalaidzidis Y, Solimena M
|
Aged insulin granules display reduced microtubule-dependent mobility and are disposed within actin-positive multigranular bodies.
|
Proc. Natl. Acad. Sci. U.S.A. 2015 Feb 17;112(7):E667-76
|
- EMF & Histo CMCB
- EMF MPI-CBG
- LMF CMCB
- LMF MPI-CBG
|
Cell Biology
|

|
25646459 |
Bayesian probability theory; diabetes; islets; processivity; secretion |
Insulin secretion is key for glucose homeostasis. Insulin secretory granules (SGs) exist in different functional pools, with young SGs being more mobile and preferentially secreted. However, the principles governing the mobility of age-distinct SGs remain undefined. Using the time-reporter insulin-SNAP to track age-distinct SGs we now show that their dynamics can be classified into three components: highly dynamic, restricted, and nearly immobile. Young SGs display all three components, whereas old SGs are either restricted or nearly immobile. Both glucose stimulation and F-actin depolymerization recruit a fraction of nearly immobile young, but not old, SGs for highly dynamic, microtubule-dependent transport. Moreover, F-actin marks multigranular bodies/lysosomes containing aged SGs. These data demonstrate that SGs lose their responsiveness to glucose stimulation and competence for microtubule-mediated transport over time while changing their relationship with F-actin. |
|
Villaseñor R, Nonaka H, Del Conte-Zerial P, Kalaidzidis Y, Zerial M
|
Regulation of EGFR signal transduction by analogue-to-digital conversion in endosomes.
|
Elife 2015 Feb 04;4
|
- LMF MPI-CBG
- Screening MPI-CBG
|
Cell Biology
|

|
25650738 |
cell biology; endocytosis; human; membrane transport; mouse; rat; signal transduction |
An outstanding question is how receptor tyrosine kinases (RTKs) determine different cell-fate decisions despite sharing the same signalling cascades. Here, we uncovered an unexpected mechanism of RTK trafficking in this process. By quantitative high-resolution FRET microscopy, we found that phosphorylated epidermal growth factor receptor (p-EGFR) is not randomly distributed but packaged at constant mean amounts in endosomes. Cells respond to higher EGF concentrations by increasing the number of endosomes but keeping the mean p-EGFR content per endosome almost constant. By mathematical modelling, we found that this mechanism confers both robustness and regulation to signalling output. Different growth factors caused specific changes in endosome number and size in various cell systems and changing the distribution of p-EGFR between endosomes was sufficient to reprogram cell-fate decision upon EGF stimulation. We propose that the packaging of p-RTKs in endosomes is a general mechanism to ensure the fidelity and specificity of the signalling response. |
|
Wieduwild R, Krishnan S, Chwalek K, Boden A, Nowak M, Drechsel D, Werner C, Zhang Y
|
Noncovalent hydrogel beads as microcarriers for cell culture.
|
Angew. Chem. Int. Ed. Engl. 2015 Mar 23;54(13):3962-6
|
|
Cell Biology
|
|
25650774 |
beads; cell encapsulation; gels; noncovalent interactions; protein release |
Hydrogel beads as microcarriers could have many applications in biotechnology. However, bead formation by noncovalent cross-linking to achieve high cell compatibility by avoiding chemical reactions remains challenging because of rapid gelation rates and/or low stability. Here we report the preparation of homogeneous, tunable, and robust hydrogel beads from peptide-polyethylene glycol conjugates and oligosaccharides under mild, cell-compatible conditions using a noncovalent crosslinking mechanism. Large proteins can be released from beads easily. Further noncovalent modification allows for bead labeling and functionalization with various compounds. High survival rates of embedded cells were achieved under standard cell culture conditions and after freezing the beads, demonstrating its suitability for encapsulating and conserving cells. Hydrogel beads as functional system have been realized by generating protein-producing microcarriers with embedded eGFP-secreting insect cells. |
|
Balyura M, Gelfgat E, Ehrhart-Bornstein M, Ludwig B, Gendler Z, Barkai U, Zimerman B, Rotem A, Block NL, Schally AV, Bornstein SR
|
Transplantation of bovine adrenocortical cells encapsulated in alginate.
|
Proc. Natl. Acad. Sci. U.S.A. 2015 Feb 24;112(8):2527-32
|
|
Medical Biology
|

|
25675525 |
LHRH; adrenal; alginate encapsulation; cell transplantation |
Current treatment options for adrenal insufficiency are limited to corticosteroid replacement therapies. However, hormone therapy does not replicate circadian rhythms and has unpleasant side effects especially due to the failure to restore normal function of the hypothalamic-pituitary-adrenal (HPA) axis. Adrenal cell transplantation and the restoration of HPA axis function would be a feasible and useful therapeutic strategy for patients with adrenal insufficiency. We created a bioartificial adrenal with 3D cell culture conditions by encapsulation of bovine adrenocortical cells (BACs) in alginate (enBACs). We found that, compared with BACs in monolayer culture, encapsulation in alginate significantly increased the life span of BACs. Encapsulation also improved significantly both the capacity of adrenal cells for stable, long-term basal hormone release as well as the response to pituitary adrenocorticotropic hormone (ACTH) and hypothalamic luteinizing hormone-releasing hormone (LHRH) agonist, [D-Trp6]LHRH. The enBACs were transplanted into adrenalectomized, immunodeficient, and immunocompetent rats. Animals received enBACs intraperitoneally, under the kidney capsule (free cells or cells encapsulated in alginate slabs) or s.c. enclosed in oxygenating and immunoisolating ?Air devices. Graft function was confirmed by the presence of cortisol in the plasma of rats. Both types of grafted encapsulated cells, explanted after 21-25 d, preserved their morphology and functional response to ACTH stimulation. In conclusion, transplantation of a bioartificial adrenal with xenogeneic cells may be a treatment option for patients with adrenocortical insufficiency and other stress-related disorders. Furthermore, this model provides a microenvironment that ensures 3D cell-cell interactions as a unique tool to investigate new insights into cell biology, differentiation, tissue organization, and homeostasis. |
|
Eugster A, Lindner A, Catani M, Heninger AK, Dahl A, Klemroth S, Kühn D, Dietz S, Bickle M, Ziegler AG, Bonifacio E
|
High diversity in the TCR repertoire of GAD65 autoantigen-specific human CD4+ T cells.
|
J. Immunol. 2015 Mar 15;194(6):2531-8
|
|
Medical Biology
|

|
25681349 |
|
Autoreactive CD4(+) T cells are an essential feature of type 1 diabetes mellitus. We applied single-cell TCR ?- and ?-chain sequencing to peripheral blood GAD65-specific CD4(+) T cells, and TCR ?-chain next-generation sequencing to bulk memory CD4(+) T cells to provide insight into TCR diversity in autoimmune diabetes mellitus. TCRs obtained for 1650 GAD65-specific CD4(+) T cells isolated from GAD65 proliferation assays and/or GAD65 557I tetramer staining in 6 patients and 10 islet autoantibody-positive children showed large diversity with 1003 different TCRs identified. TRAV and TRBV gene usage was broad, and the TRBV5.1 gene was most prominent within the GAD65 557I tetramer(+) cells. Limited overlap (<5%) was observed between TCRs of GAD65-proliferating and GAD65 557I tetramer(+) CD4(+) T cells. Few TCRs were repeatedly found in GAD65-specific cells at different time points from individual patients, and none was seen in more than one subject. However, single chains were often shared between patients and used in combination with different second chains. Next-generation sequencing revealed a wide frequency range (<0.00001-1.62%) of TCR ?-chains corresponding to GAD65-specific T cells. The findings support minor selection of genes and TCRs for GAD65-specific T cells, but fail to provide strong support for TCR-targeted therapies. |
|
Florio M, Albert M, Taverna E, Namba T, Brandl H, Lewitus E, Haffner C, Sykes A, Wong FK, Peters J, Guhr E, Klemroth S, Prüfer K, Kelso J, Naumann R, Nüsslein I, Dahl A, Lachmann R, Pääbo S, Huttner WB
|
Human-specific gene ARHGAP11B promotes basal progenitor amplification and neocortex expansion.
|
Science 2015 Mar 27;347(6229):1465-70
|
|
Developmental Biology
|

|
25721503 |
|
Evolutionary expansion of the human neocortex reflects increased amplification of basal progenitors in the subventricular zone, producing more neurons during fetal corticogenesis. In this work, we analyze the transcriptomes of distinct progenitor subpopulations isolated by a cell polarity-based approach from developing mouse and human neocortex. We identify 56 genes preferentially expressed in human apical and basal radial glia that lack mouse orthologs. Among these, ARHGAP11B has the highest degree of radial glia-specific expression. ARHGAP11B arose from partial duplication of ARHGAP11A (which encodes a Rho guanosine triphosphatase-activating protein) on the human lineage after separation from the chimpanzee lineage. Expression of ARHGAP11B in embryonic mouse neocortex promotes basal progenitor generation and self-renewal and can increase cortical plate area and induce gyrification. Hence, ARHGAP11B may have contributed to evolutionary expansion of human neocortex. |
|
Kumichel A, Kapp K, Knust E
|
A Conserved Di-Basic Motif of Drosophila Crumbs Contributes to Efficient ER Export.
|
Traffic 2015 Jun 14;16(6):604-16
|
|
Cell Biology
|

|
25753515 |
COPII; Crumbs; Drosophila; ER export; Sar1; di-basic motif |
The Drosophila type I transmembrane protein Crumbs is an apical determinant required for the maintenance of apico-basal epithelial cell polarity. The level of Crumbs at the plasma membrane is crucial, but how it is regulated is poorly understood. In a genetic screen for regulators of Crumbs protein trafficking we identified Sar1, the core component of the coat protein complex II transport vesicles. sar1 mutant embryos show a reduced plasma membrane localization of Crumbs, a defect similar to that observed in haunted and ghost mutant embryos, which lack Sec23 and Sec24CD, respectively. By pulse-chase assays in Drosophila Schneider cells and analysis of protein transport kinetics based on Endoglycosidase H resistance we identified an RNKR motif in Crumbs, which contributes to efficient ER export. The motif identified fits the highly conserved di-basic RxKR motif and mediates interaction with Sar1. The RNKR motif is also required for plasma membrane delivery of transgene-encoded Crumbs in epithelial cells of Drosophila embryos. Our data are the first to show that a di-basic motif acts as a signal for ER exit of a type I plasma membrane protein in a metazoan organism. |
|
Rappa G, Green TM, Karbanová J, Corbeil D, Lorico A
|
Tetraspanin CD9 determines invasiveness and tumorigenicity of human breast cancer cells.
|
Oncotarget 2015 Apr 10;6(10):7970-91
|
|
Medical Biology
|

|
25762645 |
CD9; breast cancer; cell invasion; plasma membrane protrusions; tetraspanin |
Interaction of breast cancer cells (BCCs) with stromal components is critical for tumor growth and metastasis. Here, we assessed the role of CD9 in adhesion, migration and invasiveness of BCCs. We used co-cultures of BCCs and bone marrow-derived multipotent mesenchymal stromal cells (MSCs), and analyzed their behavior and morphology by dynamic total internal reflection fluorescence, confocal and scanning electron microscopy. 83, 16 and 10% of contacts between MDA-MB-231 (MDA), MA-11 or MCF-7 cells and MSCs, respectively, resulted in MSC invasion. MDA cells developed long magnupodia, lamellipodia and dorsal microvilli, whereas long microvilli emerged from MA-11 cells. MCF-7 cells displayed large dorsal ruffles. CD9 knockdown and antibody blockage in MDA cells inhibited MSC invasion by 95 and 70%, respectively, suggesting that CD9 is required for this process. Remarkably, CD9-deficient MDA cells displayed significant alteration of their plasma membrane, harboring numerous peripheral and dorsal membrane ruffles instead of intact magnupodium/lamellipodium and microvillus, respectively. Such modification might explain the delayed adhesion, and hence MSC invasion. In agreement with this hypothesis, CD9-knockdown suppressed the metastatic capacity of MDA cells in mouse xenografts. Our data indicate that CD9 is implicated in BCC invasiveness and metastases by cellular mechanisms that involve specific CD9+ plasma membrane protrusions of BCCs. |
|
Glunčić M, Maghelli N, Krull A, Krstić V, Ramunno-Johnson D, Pavin N, Tolić IM
|
Kinesin-8 motors improve nuclear centering by promoting microtubule catastrophe.
|
Phys. Rev. Lett. 2015 Feb 20;114(7):078103
|
|
Biophysics
|

|
25763975 |
|
In fission yeast, microtubules push against the cell edge, thereby positioning the nucleus in the cell center. Kinesin-8 motors regulate microtubule catastrophe; however, their role in nuclear positioning is not known. Here we develop a physical model that describes how kinesin-8 motors affect nuclear centering by promoting a microtubule catastrophe. Our model predicts the improved centering of the nucleus in the presence of motors, which we confirmed experimentally in living cells. The model also predicts a characteristic time for the recentering of a displaced nucleus, which is supported by our experiments where we displaced the nucleus using optical tweezers. |
|
Bergert M, Erzberger A, Desai RA, Aspalter IM, Oates AC, Charras G, Salbreux G, Paluch EK
|
Force transmission during adhesion-independent migration.
|
Nat. Cell Biol. 2015 Apr 16;17(4):524-9
|
|
Biophysics
|

|
25774834 |
|
When cells move using integrin-based focal adhesions, they pull in the direction of motion with large, ?100 Pa, stresses that contract the substrate. Integrin-mediated adhesions, however, are not required for in vivo confined migration. During focal adhesion-free migration, the transmission of propelling forces, and their magnitude and orientation, are not understood. Here, we combine theory and experiments to investigate the forces involved in adhesion-free migration. Using a non-adherent blebbing cell line as a model, we show that actin cortex flows drive cell movement through nonspecific substrate friction. Strikingly, the forces propelling the cell forward are several orders of magnitude lower than during focal-adhesion-based motility. Moreover, the force distribution in adhesion-free migration is inverted: it acts to expand, rather than contract, the substrate in the direction of motion. This fundamentally different mode of force transmission may have implications for cell-cell and cell-substrate interactions during migration in vivo. |
|
Rubin de Celis MF, Garcia-Martin R, Wittig D, Valencia GD, Enikolopov G, Funk RH, Chavakis T, Bornstein SR, Androutsellis-Theotokis A, Ehrhart-Bornstein M
|
Multipotent glia-like stem cells mediate stress adaptation.
|
Stem Cells 2015 Jun 21;33(6):2037-51
|
|
Neurobiology
|

|
25802118 |
Adrenal medulla; Adult stem cells; Lineage tracing; Nestin; Neural stem cell-like cells; Plasticity; Stress; Sustentacular cells |
The neural crest-derived adrenal medulla is closely related to the sympathetic nervous system; however, unlike neural tissue, it is characterized by high plasticity which suggests the involvement of stem cells. Here, we show that a defined pool of glia-like nestin-expressing progenitor cells in the adult adrenal medulla contributes to this plasticity. These glia-like cells have features of adrenomedullary sustentacular cells, are multipotent, and are able to differentiate into chromaffin cells and neurons. The adrenal is central to the body's response to stress making its proper adaptation critical to maintaining homeostasis. Our results from stress experiments in vivo show the activation and differentiation of these progenitors into new chromaffin cells. In summary, we demonstrate the involvement of a new glia-like multipotent stem cell population in adrenal tissue adaptation. Our data also suggest the contribution of stem and progenitor cells in the adaptation of neuroendocrine tissue function in general. |
|
Paridaen JT, Huttner WB, Wilsch-Bräuninger M
|
Analysis of primary cilia in the developing mouse brain.
|
Methods Cell Biol. 2015 Feb 14;127:93-129
|
|
Developmental Biology
|

|
25837388 |
Asymmetry; Cell division; Ciliogenesis; Neurogenesis; Primary cilium; Stem and progenitor cells |
Stem and progenitor cells in the developing mammalian brain are highly polarized cells that carry a primary cilium protruding into the brain ventricles. Here, cilia detect signals present in the cerebrospinal fluid that fills the ventricles. Recently, striking observations have been made regarding the dynamics of primary cilia in mitosis and cilium reformation after cell division. In neural progenitors, primary cilia are not completely disassembled during cell division, and some ciliary membrane remnant can be inherited by one daughter cell that tends to maintain a progenitor fate. Furthermore, newborn differentiating cells grow a primary cilium on their basolateral plasma membrane, in spite of them possessing apical membrane and adherens junctions, and thus change the environment to which the primary cilium is exposed. These phenomena are proposed to be involved in cell fate determination and delamination of daughter cells in conjunction with the production of neurons. Here, we describe several methods that can be used to study the structure, localization, and dynamics of primary cilia in the developing mouse brain; these include time-lapse imaging of live mouse embryonic brain tissues, and analysis of primary cilia structure and localization using correlative light- and electron- and serial-block-face scanning electron microscopy. |
|
McShane MP, Friedrichson T, Giner A, Meyenhofer F, Barsacchi R, Bickle M, Zerial M
|
A Combination of Screening and Computational Approaches for the Identification of Novel Compounds That Decrease Mast Cell Degranulation.
|
J Biomol Screen 2015 Jul 02;20(6):720-8
|
- LMF MPI-CBG
- Screening MPI-CBG
|
Medical Biology
|

|
25838434 |
Akt; mast cell; phosphorylation; screening |
High-content screening of compound libraries poses various challenges in the early steps in drug discovery such as gaining insights into the mode of action of the selected compounds. Here, we addressed these challenges by integrating two biological screens through bioinformatics and computational analysis. We screened a small-molecule library enriched in amphiphilic compounds in a degranulation assay in rat basophilic leukemia 2H3 (RBL-2H3) cells. The same library was rescreened in a high-content image-based endocytosis assay in HeLa cells. This assay was previously applied to a genome-wide RNAi screen that produced quantitative multiparametric phenotypic profiles for genes that directly or indirectly affect endocytosis. By correlating the endocytic profiles of the compounds with the genome-wide siRNA profiles, we identified candidate pathways that may be inhibited by the compounds. Among these, we focused on the Akt pathway and validated its inhibition in HeLa and RBL-2H3 cells. We further showed that the compounds inhibited the translocation of the Akt-PH domain to the plasma membrane. The approach performed here can be used to integrate chemical and functional genomics screens for investigating the mechanism of action of compounds. |
|
Sinningen K, Albus E, Thiele S, Grossklaus S, Kurth T, Udey MC, Chavakis T, Hofbauer LC, Rauner M
|
Loss of milk fat globule-epidermal growth factor 8 (MFG-E8) in mice leads to low bone mass and accelerates ovariectomy-associated bone loss by increasing osteoclastogenesis.
|
Bone 2015 Jul 11;76:107-14
|
|
Medical Biology
|

|
25868798 |
Bone homeostasis; MFG-E8; Osteoblast; Osteoclast |
Milk fat globule-epidermal growth factor 8 (MFG-E8) is a glycoprotein that controls the engulfment of apoptotic cells and exerts inflammation-modulatory effects. Recently, it has been implicated in osteoclastogenesis and the pathogenesis of inflammatory periodontal bone loss, but its role in physiological bone homeostasis is still not well defined. Here, we evaluated the influence of MFG-E8 on osteoblasts and osteoclasts and its impact on bone remodeling in healthy and ovariectomized mice as a model for post-menopausal osteoporosis. Total and trabecular bone mineral densities at the lumbar spine in 6-week-old MFG-E8 KO mice were reduced by 11% (p < 0.05) and 17% (p < 0.01), respectively, as compared to wild-type (WT) mice. Accordingly, serum levels of the bone formation marker P1NP were decreased by 37% (p < 0.01) in MFG-E8 KO mice as were the ex vivo mineralization capacity and expression of osteoblast genes (Runx2, alkaline phosphatase, osteocalcin) in MFG-E8 KO osteoblasts. In contrast, serum bone resorption markers CTX1 and TRAP5b were increased by 30% and 60% (p < 0.05), respectively, in MFG-E8 KO mice. Furthermore, bone marrow macrophages from MFG-E8-KO mice differentiated more effectively into osteoclasts, as compared to WT cells. MFG-E8-deficient osteoclasts displayed increased bone resorption ex vivo, which could be reversed by the presence of recombinant MFG-E8. To determine the significance of the enhanced osteoclastogenesis in MFG-E8 KO mice, we performed an ovariectomy, which is associated with bone loss due to increased osteoclast activity. Indeed, MFG-E8 KO mice lost 12% more trabecular bone density than WT mice after ovariectomy. Together, these data indicate that MFG-E8 controls steady-state and pathological bone turnover and may therefore represent a new target gene in the treatment of bone diseases. |
|
Czogalla A, Kauert DJ, Franquelim HG, Uzunova V, Zhang Y, Seidel R, Schwille P
|
Amphipathic DNA origami nanoparticles to scaffold and deform lipid membrane vesicles.
|
Angew. Chem. Int. Ed. Engl. 2015 May 26;54(22):6501-5
|
|
Biophysics
|

|
25882792 |
diffusion; lipid membranes; membrane deformation; oligomerization; origami DNA structures |
We report a synthetic biology-inspired approach for the engineering of amphipathic DNA origami structures as membrane-scaffolding tools. The structures have a flat membrane-binding interface decorated with cholesterol-derived anchors. Sticky oligonucleotide overhangs on their side facets enable lateral interactions leading to the formation of ordered arrays on the membrane. Such a tight and regular arrangement makes our DNA origami capable of deforming free-standing lipid membranes, mimicking the biological activity of coat-forming proteins, for example, from the I-/F-BAR family. |
|
Kizil C, Iltzsche A, Thomas AK, Bhattarai P, Zhang Y, Brand M
|
Efficient Cargo Delivery into Adult Brain Tissue Using Short Cell-Penetrating Peptides.
|
PLoS ONE 2015 Apr 20;10(4):e0124073
|
|
Cell Biology
|

|
25894337 |
|
Zebrafish brains can regenerate lost neurons upon neurogenic activity of the radial glial progenitor cells (RGCs) that reside at the ventricular region. Understanding the molecular events underlying this ability is of great interest for translational studies of regenerative medicine. Therefore, functional analyses of gene function in RGCs and neurons are essential. Using cerebroventricular microinjection (CVMI), RGCs can be targeted efficiently but the penetration capacity of the injected molecules reduces dramatically in deeper parts of the brain tissue, such as the parenchymal regions that contain the neurons. In this report, we tested the penetration efficiency of five known cell-penetrating peptides (CPPs) and identified two- polyR and Trans - that efficiently penetrate the brain tissue without overt toxicity in a dose-dependent manner as determined by TUNEL staining and L-Plastin immunohistochemistry. We also found that polyR peptide can help carry plasmid DNA several cell diameters into the brain tissue after a series of coupling reactions using DBCO-PEG4-maleimide-based Michael's addition and azide-mediated copper-free click reaction. Combined with the advantages of CVMI, such as rapidness, reproducibility, and ability to be used in adult animals, CPPs improve the applicability of the CVMI technique to deeper parts of the central nervous system tissues. |
|
Sezgin E, Gutmann T, Buhl T, Dirkx R, Grzybek M, Coskun Ü, Solimena M, Simons K, Levental I, Schwille P
|
Adaptive lipid packing and bioactivity in membrane domains.
|
PLoS ONE 2015 Apr 23;10(4):e0123930
|
|
Biophysics
|

|
25905447 |
|
Lateral compositional and physicochemical heterogeneity is a ubiquitous feature of cellular membranes on various length scales, from molecular assemblies to micrometric domains. Segregated lipid domains of increased local order, referred to as rafts, are believed to be prominent features in eukaryotic plasma membranes; however, their exact nature (i.e. size, lifetime, composition, homogeneity) in live cells remains difficult to define. Here we present evidence that both synthetic and natural plasma membranes assume a wide range of lipid packing states with varying levels of molecular order. These states may be adapted and specifically tuned by cells during active cellular processes, as we show for stimulated insulin secretion. Most importantly, these states regulate both the partitioning of molecules between coexisting domains and the bioactivity of their constituent molecules, which we demonstrate for the ligand binding activity of the glycosphingolipid receptor GM1. These results confirm the complexity and flexibility of lipid-mediated membrane organization and reveal mechanisms by which this flexibility could be functionalized by cells. |
|
Zeigerer A, Bogorad RL, Sharma K, Gilleron J, Seifert S, Sales S, Berndt N, Bulik S, Marsico G, D'Souza RC, Lakshmanaperumal N, Meganathan K, Natarajan K, Sachinidis A, Dahl A, Holzhütter HG, Shevchenko A, Mann M, Koteliansky V, Zerial M
|
Regulation of liver metabolism by the endosomal GTPase Rab5.
|
Cell Rep 2015 May 12;11(6):884-92
|
|
Cell Biology
|

|
25937276 |
|
The liver maintains glucose and lipid homeostasis by adapting its metabolic activity to the energy needs of the organism. Communication between hepatocytes and extracellular environment via endocytosis is key to such homeostasis. Here, we addressed the question of whether endosomes are required for gluconeogenic gene expression. We took advantage of the loss of endosomes in the mouse liver upon Rab5 silencing. Strikingly, we found hepatomegaly and severe metabolic defects such as hypoglycemia, hypercholesterolemia, hyperlipidemia, and glycogen accumulation that phenocopied those found in von Gierke's disease, a glucose-6-phosphatase (G6Pase) deficiency. G6Pase deficiency alone can account for the reduction in hepatic glucose output and glycogen accumulation as determined by mathematical modeling. Interestingly, we uncovered functional alterations in the transcription factors, which regulate G6Pase expression. Our data highlight a requirement of Rab5 and the endosomal system for the regulation of gluconeogenic gene expression that has important implications for metabolic diseases. |
|
Malinovska L, Palm S, Gibson K, Verbavatz JM, Alberti S
|
Dictyostelium discoideum has a highly Q/N-rich proteome and shows an unusual resilience to protein aggregation.
|
Proc. Natl. Acad. Sci. U.S.A. 2015 May 19;112(20):E2620-9
|
|
Cell Biology
|

|
25941378 |
Dictyostelium discoideum; molecular chaperones; prion; protein aggregation; proteostasis |
Many protein-misfolding diseases are caused by proteins carrying prion-like domains. These proteins show sequence similarity to yeast prion proteins, which can interconvert between an intrinsically disordered and an aggregated prion state. The natural presence of prions in yeast has provided important insight into disease mechanisms and cellular proteostasis. However, little is known about prions in other organisms, and it is not yet clear whether the findings in yeast can be generalized. Using bioinformatics tools, we show that Dictyostelium discoideum has the highest content of prion-like proteins of all organisms investigated to date, suggesting that its proteome has a high overall aggregation propensity. To study mechanisms regulating these proteins, we analyze the behavior of several well-characterized prion-like proteins, such as an expanded version of human huntingtin exon 1 (Q103) and the prion domain of the yeast prion protein Sup35 (NM), in D. discoideum. We find that these proteins remain soluble and are innocuous to D. discoideum, in contrast to other organisms, where they form cytotoxic cytosolic aggregates. However, when exposed to conditions that compromise molecular chaperones, these proteins aggregate and become cytotoxic. We show that the disaggregase Hsp101, a molecular chaperone of the Hsp100 family, dissolves heat-induced aggregates and promotes thermotolerance. Furthermore, prion-like proteins accumulate in the nucleus, where they are targeted by the ubiquitin-proteasome system. Our data suggest that D. discoideum has undergone specific adaptations that increase the proteostatic capacity of this organism and allow for an efficient regulation of its prion-like proteome. |
|
Dunst S, Kazimiers T, von Zadow F, Jambor H, Sagner A, Brankatschk B, Mahmoud A, Spannl S, Tomancak P, Eaton S, Brankatschk M
|
Endogenously tagged rab proteins: a resource to study membrane trafficking in Drosophila.
|
Dev. Cell 2015 May 4;33(3):351-65
|
|
Developmental Biology
|

|
25942626 |
|
Membrane trafficking is key to the cell biological mechanisms underlying development. Rab GTPases control specific membrane compartments, from core secretory and endocytic machinery to less-well-understood compartments. We tagged all 27 Drosophila Rabs with YFP(MYC) at their endogenous chromosomal loci, determined their expression and subcellular localization in six tissues comprising 23 cell types, and provide this data in an annotated, searchable image database. We demonstrate the utility of these lines for controlled knockdown and show that similar subcellular localization can predict redundant functions. We exploit this comprehensive resource to ask whether a common Rab compartment architecture underlies epithelial polarity. Strikingly, no single arrangement of Rabs characterizes the five epithelia we examine. Rather, epithelia flexibly polarize Rab distribution, producing membrane trafficking architectures that are tissue- and stage-specific. Thus, the core machinery responsible for epithelial polarization is unlikely to rely on polarized positioning of specific Rab compartments. |
|
Löffler K, Schäfer P, Völkner M, Holdt T, Karl MO
|
Age-dependent Müller glia neurogenic competence in the mouse retina.
|
Glia 2015 Oct 06;63(10):1809-24
|
|
Cell Biology
|

|
25943952 |
gliosis; mice; neuroglia; regeneration; reprogramming; stem cells |
The mechanisms limiting neuronal regeneration in mammals and their relationship with reactive gliosis are unknown. Müller glia (MG), common to all vertebrate retinas, readily regenerate neuron loss in some species, but normally not in mammals. However, experimental stimulation of limited mammalian retina regeneration has been reported. Here, we use a mouse retina organ culture approach to investigate the MG responses at different mouse ages. We found that MG undergo defined spatio-temporal changes upon stimulation. In EGF-stimulated juvenile postmitotic retinas, most MG upregulate cell-cycle regulators (Mcm6, Pcna, Ki67, Ccnd1) within 48 h ex vivo; some also express the neurogenic factors Ascl1, Pax6, and Vsx2; up to 60% re-enter the cell cycle, some of which delaminate to divide mostly apically; and the majority cease to proliferate after stimulation. A subpopulation of MG progeny starts to express transcription factors (Ptf1a, Nr4a2) and neuronal (Calb1, Calb2, Rbfox3), but not glial, markers, indicating neurogenesis. BrdU-tracking, genetic lineage-tracing, and transgenic-reporter experiments suggest that MG reprogram to a neurogenic stage and proliferate; and that some MG progeny differentiate into neuronal-like cells, most likely amacrines, no photoreceptors; most others remain in a de-differentiated state. The mouse MG regeneration potential becomes restricted, dependent on the age of the animal, as observed by limited activation of the cell cycle and neurogenic factors. The stage-dependent analysis of mouse MG revealed similarities and differences when compared with MG-derived regeneration in fish and chicks. Therefore, the mouse retina ex vivo approach is a potential assay for understanding and overcoming the limitations of mammalian MG-derived neuronal regeneration. Postmitotic MG in mouse retina ex vivo can be stimulated to proliferate, express neurogenic factors, and generate progeny expressing neuronal or glial markers. This potential regenerative competence becomes limited with increasing mouse age. |
|
Turrero García M, Chang Y, Arai Y, Huttner WB
|
S-phase duration is the main target of cell cycle regulation in neural progenitors of developing ferret neocortex.
|
J. Comp. Neurol. 2016 Feb 15;524(3):456-70
|
|
Developmental Biology
|

|
25963823 |
AB_10569705; AB_10615604; AB_2142367; AB_2295065; AB_778267; AB_95106; RRIDs: AB_2313780; SciRes_000137; cortical development; evolution; gyrencephaly; neurogenesis; nif-0000-30467 |
The evolutionary expansion of the neocortex primarily reflects increases in abundance and proliferative capacity of cortical progenitors and in the length of the neurogenic period during development. Cell cycle parameters of neocortical progenitors are an important determinant of cortical development. The ferret (Mustela putorius furo), a gyrencephalic mammal, has gained increasing importance as a model for studying corticogenesis. Here, we have studied the abundance, proliferation, and cell cycle parameters of different neural progenitor types, defined by their differential expression of the transcription factors Pax6 and Tbr2, in the various germinal zones of developing ferret neocortex. We focused our analyses on postnatal day 1, a late stage of cortical neurogenesis when upper-layer neurons are produced. Based on cumulative 5-ethynyl-2'-deoxyuridine (EdU) labeling as well as Ki67 and proliferating cell nuclear antigen (PCNA) immunofluorescence, we determined the duration of the various cell cycle phases of the different neocortical progenitor subpopulations. Ferret neocortical progenitors were found to exhibit longer cell cycles than those of rodents and little variation in the duration of G1 among distinct progenitor types, also in contrast to rodents. Remarkably, the main difference in cell cycle parameters among the various progenitor types was the duration of S-phase, which became shorter as progenitors progressively changed transcription factor expression from patterns characteristic of self-renewal to those of neuron production. Hence, S-phase duration emerges as major target of cell cycle regulation in cortical progenitors of this gyrencephalic mammal. |
|
Woodruff JB, Wueseke O, Viscardi V, Mahamid J, Ochoa SD, Bunkenborg J, Widlund PO, Pozniakovsky A, Zanin E, Bahmanyar S, Zinke A, Hong SH, Decker M, Baumeister W, Andersen JS, Oegema K, Hyman AA
|
Centrosomes. Regulated assembly of a supramolecular centrosome scaffold in vitro.
|
Science 2015 May 15;348(6236):808-12
|
|
Cell Biology
|

|
25977552 |
|
The centrosome organizes microtubule arrays within animal cells and comprises two centrioles surrounded by an amorphous protein mass called the pericentriolar material (PCM). Despite the importance of centrosomes as microtubule-organizing centers, the mechanism and regulation of PCM assembly are not well understood. In Caenorhabditis elegans, PCM assembly requires the coiled-coil protein SPD-5. We found that recombinant SPD-5 could polymerize to form micrometer-sized porous networks in vitro. Network assembly was accelerated by two conserved regulators that control PCM assembly in vivo, Polo-like kinase-1 and SPD-2/Cep192. Only the assembled SPD-5 networks, and not unassembled SPD-5 protein, functioned as a scaffold for other PCM proteins. Thus, PCM size and binding capacity emerge from the regulated polymerization of one coiled-coil protein to form a porous network. |
|
Cho B, Pierre-Louis G, Sagner A, Eaton S, Axelrod JD
|
Clustering and negative feedback by endocytosis in planar cell polarity signaling is modulated by ubiquitinylation of prickle.
|
PLoS Genet. 2015 May 21;11(5):e1005259
|
|
Cell Biology
|

|
25996914 |
|
The core components of the planar cell polarity (PCP) signaling system, including both transmembrane and peripheral membrane associated proteins, form asymmetric complexes that bridge apical intercellular junctions. While these can assemble in either orientation, coordinated cell polarization requires the enrichment of complexes of a given orientation at specific junctions. This might occur by both positive and negative feedback between oppositely oriented complexes, and requires the peripheral membrane associated PCP components. However, the molecular mechanisms underlying feedback are not understood. We find that the E3 ubiquitin ligase complex Cullin1(Cul1)/SkpA/Supernumerary limbs(Slimb) regulates the stability of one of the peripheral membrane components, Prickle (Pk). Excess Pk disrupts PCP feedback and prevents asymmetry. We show that Pk participates in negative feedback by mediating internalization of PCP complexes containing the transmembrane components Van Gogh (Vang) and Flamingo (Fmi), and that internalization is activated by oppositely oriented complexes within clusters. Pk also participates in positive feedback through an unknown mechanism promoting clustering. Our results therefore identify a molecular mechanism underlying generation of asymmetry in PCP signaling. |
|
Nicola Z, Fabel K, Kempermann G
|
Development of the adult neurogenic niche in the hippocampus of mice.
|
Front Neuroanat 2015 May 07;9:53
|
|
Neurobiology
|

|
25999820 |
adult neurogenesis; dentate gyrus; hippocampus; mouse models; plasticity; precursor cells; stem cell; subgranular zone |
When does adult hippocampal neurogenesis begin? We describe the development of the neurogenic niche in the subgranular zone (SGZ) of the hippocampal dentate gyrus. We did so from the perspective of the situation in the adult. Ontogeny of the dentate gyrus is complex and results in an ectopic neurogenic niche that lifelong generates new granule cells. Neurogenesis during the fetal and early postnatal periods builds the dentate gyrus and gives way to activity-dependent "adult" neurogenesis. We used markers most relevant to adult neurogenesis research to describe this transition: Nestin, Sox2, BLBP, GFAP, Tbr2, Doublecortin (DCX), NeuroD1 and Prox1. We found that massive changes and a local condensation of proliferating precursor cells occurs between postnatal day 7 (P7), near the peak in proliferation, and P14. Before and around P7, the spatial distribution of cells and the co-localization of markers were distinct from the situation in the adult. Unlike the adult SGZ, the marker pair Nestin/Sox2 and the radial glial marker BLBP were not overlapping during embryonic development, presumably indicating different types of radial glia-like cells. Before P7 GFAP-positive cells in the hilus lacked the radial orientation that is characteristic of the adult type-1 cells. DCX, which is concentrated in type-2b and type-3 progenitor cells and early postmitotic neurons in the adult, showed diffuse expression before P7. Intermediate progenitor cell marker Tbr2 became restricted to the SGZ but was found in the granule cell layer (GCL) and hilus before. Lineage markers NeuroD1 and Prox1 confirmed this pattern. We conclude that the neurogenic niche of adult neurogenesis is in place well before true adulthood. This might indicate that consistent with the hypothesized function of adult neurogenesis in activity-dependent plasticity, the early transition from postnatal neurogenesis to adult neurogenesis coincides with the time, when the young mice start to become active themselves. |
|
Elbaum-Garfinkle S, Kim Y, Szczepaniak K, Chen CC, Eckmann CR, Myong S, Brangwynne CP
|
The disordered P granule protein LAF-1 drives phase separation into droplets with tunable viscosity and dynamics.
|
Proc. Natl. Acad. Sci. U.S.A. 2015 Jun 9;112(23):7189-94
|
|
Biophysics
|

|
26015579 |
RNA granules; intracellular phase transition; intrinsically disordered proteins; liquid droplets |
P granules and other RNA/protein bodies are membrane-less organelles that may assemble by intracellular phase separation, similar to the condensation of water vapor into droplets. However, the molecular driving forces and the nature of the condensed phases remain poorly understood. Here, we show that the Caenorhabditis elegans protein LAF-1, a DDX3 RNA helicase found in P granules, phase separates into P granule-like droplets in vitro. We adapt a microrheology technique to precisely measure the viscoelasticity of micrometer-sized LAF-1 droplets, revealing purely viscous properties highly tunable by salt and RNA concentration. RNA decreases viscosity and increases molecular dynamics within the droplet. Single molecule FRET assays suggest that this RNA fluidization results from highly dynamic RNA-protein interactions that emerge close to the droplet phase boundary. We demonstrate than an N-terminal, arginine/glycine rich, intrinsically disordered protein (IDP) domain of LAF-1 is necessary and sufficient for both phase separation and RNA-protein interactions. In vivo, RNAi knockdown of LAF-1 results in the dissolution of P granules in the early embryo, with an apparent submicromolar phase boundary comparable to that measured in vitro. Together, these findings demonstrate that LAF-1 is important for promoting P granule assembly and provide insight into the mechanism by which IDP-driven molecular interactions give rise to liquid phase organelles with tunable properties. |
|
Heymann MC, Rabe S, Ruß S, Kapplusch F, Schulze F, Stein R, Winkler S, Hedrich CM, Rösen-Wolff A, Hofmann SR
|
Fluorescent tags influence the enzymatic activity and subcellular localization of procaspase-1.
|
Clin. Immunol. 2015 Oct 27;160(2):172-9
|
|
Cell Biology
|

|
26025004 |
CARD; Caspase-1; Fluorescent fusion protein; IL-1?; Inflammasome; mCherry |
Subcellular localization studies and life cell imaging approaches usually benefit from fusion-reporter proteins, such as enhanced green fluorescent protein (EGFP) and mCherry to the proteins of interest. However, such manipulations have several risks, including protein misfolding, altered protein shuttling, or functional impairment when compared to the wild-type proteins. Here, we demonstrate altered subcellular distribution and function of the pro-inflammatory enzyme procaspase-1 as a result of fusion with the reporter protein mCherry. Our observations are of central importance to further investigations of subcellular behavior and possible protein-protein interactions of naturally occurring genetic variants of human procaspase-1 which have recently been linked to autoinflammatory disorders. |
|
Etournay R, Popović M, Merkel M, Nandi A, Blasse C, Aigouy B, Brandl H, Myers G, Salbreux G, Jülicher F, Eaton S
|
Interplay of cell dynamics and epithelial tension during morphogenesis of the Drosophila pupal wing.
|
Elife 2015 Jun 23;4:e07090
|
|
Developmental Biology
|

|
26102528 |
D. melanogaster; Drosophila; cell biology; cell-dynamics; computational biology; continuum-mechanics; morphogenesis; systems biology; tissue-mechanics; wing-epithelium |
How tissue shape emerges from the collective mechanical properties and behavior of individual cells is not understood. We combine experiment and theory to study this problem in the developing wing epithelium of Drosophila. At pupal stages, the wing-hinge contraction contributes to anisotropic tissue flows that reshape the wing blade. Here, we quantitatively account for this wing-blade shape change on the basis of cell divisions, cell rearrangements and cell shape changes. We show that cells both generate and respond to epithelial stresses during this process, and that the nature of this interplay specifies the pattern of junctional network remodeling that changes wing shape. We show that patterned constraints exerted on the tissue by the extracellular matrix are key to force the tissue into the right shape. We present a continuum mechanical model that quantitatively describes the relationship between epithelial stresses and cell dynamics, and how their interplay reshapes the wing. |
|
Gilleron J, Paramasivam P, Zeigerer A, Querbes W, Marsico G, Andree C, Seifert S, Amaya P, Stöter M, Koteliansky V, Waldmann H, Fitzgerald K, Kalaidzidis Y, Akinc A, Maier MA, Manoharan M, Bickle M, Zerial M
|
Identification of siRNA delivery enhancers by a chemical library screen.
|
Nucleic Acids Res. 2015 Sep 18;43(16)
|
- EMF MPI-CBG
- LMF MPI-CBG
- Screening MPI-CBG
|
Cell Biology
|

|
26220182 |
|
Most delivery systems for small interfering RNA therapeutics depend on endocytosis and release from endo-lysosomal compartments. One approach to improve delivery is to identify small molecules enhancing these steps. It is unclear to what extent such enhancers can be universally applied to different delivery systems and cell types. Here, we performed a compound library screen on two well-established siRNA delivery systems, lipid nanoparticles and cholesterol conjugated-siRNAs. We identified fifty-one enhancers improving gene silencing 2-5 fold. Strikingly, most enhancers displayed specificity for one delivery system only. By a combination of quantitative fluorescence and electron microscopy we found that the enhancers substantially differed in their mechanism of action, increasing either endocytic uptake or release of siRNAs from endosomes. Furthermore, they acted either on the delivery system itself or the cell, by modulating the endocytic system via distinct mechanisms. Interestingly, several compounds displayed activity on different cell types. As proof of principle, we showed that one compound enhanced siRNA delivery in primary endothelial cells in vitro and in the endocardium in the mouse heart. This study suggests that a pharmacological approach can improve the delivery of siRNAs in a system-specific fashion, by exploiting distinct mechanisms and acting upon multiple cell types. |
|
Kroschwald S, Maharana S, Mateju D, Malinovska L, Nüske E, Poser I, Richter D, Alberti S
|
Promiscuous interactions and protein disaggregases determine the material state of stress-inducible RNP granules.
|
Elife 2015 Aug 04;4:e06807
|
|
Cell Biology
|

|
26238190 |
P body; S. cerevisiae; biochemistry; cell biology; chaperones; human; phase separation; prion-like protein; protein aggregation; stress granule |
RNA-protein (RNP) granules have been proposed to assemble by forming solid RNA/protein aggregates or through phase separation into a liquid RNA/protein phase. Which model describes RNP granules in living cells is still unclear. In this study, we analyze P bodies in budding yeast and find that they have liquid-like properties. Surprisingly, yeast stress granules adopt a different material state, which is reminiscent of solid protein aggregates and controlled by protein disaggregases. By using an assay to ectopically nucleate RNP granules, we further establish that RNP granule formation does not depend on amyloid-like aggregation but rather involves many promiscuous interactions. Finally, we show that stress granules have different properties in mammalian cells, where they show liquid-like behavior. Thus, we propose that the material state of RNP granules is flexible and that the solid state of yeast stress granules is an adaptation to extreme environments, made possible by the presence of a powerful disaggregation machine. |
|
Wong FK, Fei JF, Mora-Bermúdez F, Taverna E, Haffner C, Fu J, Anastassiadis K, Stewart AF, Huttner WB
|
Sustained Pax6 Expression Generates Primate-like Basal Radial Glia in Developing Mouse Neocortex.
|
PLoS Biol. 2015 Aug 07;13(8):e1002217
|
|
Developmental Biology
|

|
26252244 |
|
The evolutionary expansion of the neocortex in mammals has been linked to enlargement of the subventricular zone (SVZ) and increased proliferative capacity of basal progenitors (BPs), notably basal radial glia (bRG). The transcription factor Pax6 is known to be highly expressed in primate, but not mouse, BPs. Here, we demonstrate that sustaining Pax6 expression selectively in BP-genic apical radial glia (aRG) and their BP progeny of embryonic mouse neocortex suffices to induce primate-like progenitor behaviour. Specifically, we conditionally expressed Pax6 by in utero electroporation using a novel, Tis21-CreERT2 mouse line. This expression altered aRG cleavage plane orientation to promote bRG generation, increased cell-cycle re-entry of BPs, and ultimately increased upper-layer neuron production. Upper-layer neuron production was also increased in double-transgenic mouse embryos with sustained Pax6 expression in the neurogenic lineage. Strikingly, increased BPs existed not only in the SVZ but also in the intermediate zone of the neocortex of these double-transgenic mouse embryos. In mutant mouse embryos lacking functional Pax6, the proportion of bRG among BPs was reduced. Our data identify specific Pax6 effects in BPs and imply that sustaining this Pax6 function in BPs could be a key aspect of SVZ enlargement and, consequently, the evolutionary expansion of the neocortex. |
|
Lojewski X, Srimasorn S, Rauh J, Francke S, Wobus M, Taylor V, Araúzo-Bravo MJ, Hallmeyer-Elgner S, Kirsch M, Schwarz S, Schwarz J, Storch A, Hermann A
|
Perivascular Mesenchymal Stem Cells From the Adult Human Brain Harbor No Instrinsic Neuroectodermal but High Mesodermal Differentiation Potential.
|
Stem Cells Transl Med 2015 Oct 24;4(10):1223-33
|
|
Medical Biology
|

|
26304036 |
Brain pericytes; Brain perivascular cells; Hippocampus; Monolayer culture; Neural progenitor cells; White matter |
Brain perivascular cells have recently been identified as a novel mesodermal cell type in the human brain. These cells reside in the perivascular niche and were shown to have mesodermal and, to a lesser extent, tissue-specific differentiation potential. Mesenchymal stem cells (MSCs) are widely proposed for use in cell therapy in many neurological disorders; therefore, it is of importance to better understand the "intrinsic" MSC population of the human brain. We systematically characterized adult human brain-derived pericytes during in vitro expansion and differentiation and compared these cells with fetal and adult human brain-derived neural stem cells (NSCs) and adult human bone marrow-derived MSCs. We found that adult human brain pericytes, which can be isolated from the hippocampus and from subcortical white matter, are-in contrast to adult human NSCs-easily expandable in monolayer cultures and show many similarities to human bone marrow-derived MSCs both regarding both surface marker expression and after whole transcriptome profile. Human brain pericytes showed a negligible propensity for neuroectodermal differentiation under various differentiation conditions but efficiently generated mesodermal progeny. Consequently, human brain pericytes resemble bone marrow-derived MSCs and might be very interesting for possible autologous and endogenous stem cell-based treatment strategies and cell therapeutic approaches for treating neurological diseases. |
|
Kurgonaite K, Gandhi H, Kurth T, Pautot S, Schwille P, Weidemann T, Bökel C
|
Essential role of endocytosis for interleukin-4-receptor-mediated JAK/STAT signalling.
|
J. Cell. Sci. 2015 Oct 15;128(20):3781-95
|
- EMF & Histo CMCB
- LMF CMCB
|
Cell Biology
|

|
26306492 |
Cytokine receptor; Dimerization; IL-13; IL-13R?1; IL-2R?; IL-4; IL-4R?; JAK3; Pak1; Pak2; Rac1 |
Many important signalling cascades operate through specialized signalling endosomes, but a corresponding mechanism has as yet not been described for hematopoietic cytokine receptors. Based on live-cell affinity measurements, we recently proposed that ligand-induced interleukin-4 receptor (IL-4R) complex formation and thus JAK/STAT pathway activation requires a local subcellular increase in receptor density. Here, we show that this concentration step is provided by the internalization of IL-4R subunits through a constitutive, Rac1-, Pak- and actin-mediated endocytosis route that causes IL-4R subunits to become enriched by about two orders of magnitude within a population of cortical endosomes. Consistently, ligand-induced receptor dimers are preferentially detected within these endosomes. IL-4 signalling can be blocked by pharmacological inhibitors targeting the actin polymerization machinery driving receptor internalization, placing endocytosis unambigously upstream of receptor activation. Taken together, these observations demonstrate a role for endocytosis that is mechanistically distinct from the scaffolding function of signalling endosomes in other pathways. |
|
Economopoulou M, Avramovic N, Klotzsche-von Ameln A, Korovina I, Sprott D, Samus M, Gercken B, Troullinaki M, Grossklaus S, Funk RH, Li X, Imhof BA, Orlova VV, Chavakis T
|
Endothelial-specific deficiency of Junctional Adhesion Molecule-C promotes vessel normalisation in proliferative retinopathy.
|
Thromb. Haemost. 2015 Nov 25;114(6):1241-9
|
|
Medical Biology
|

|
26311310 |
JAM-C; angiogenesis; endothelial cells; proliferative retinopathy |
In proliferative retinopathies, like proliferative diabetic retinopathy and retinopathy of prematurity (ROP), the hypoxia response is sustained by the failure of the retina to revascularise its ischaemic areas. Non-resolving retina ischaemia/hypoxia results in upregulation of pro-angiogenic factors and pathologic neovascularisation with ectopic, fragile neovessels. Promoting revascularisation of the retinal avascular area could interfere with this vicious cycle and lead to vessel normalisation. Here, we examined the function of endothelial junctional adhesion molecule-C (JAM-C) in the context of ROP. Endothelial-specific JAM-C-deficient (EC-JAM-C KO) mice and littermate JAM-C-proficient (EC-JAM-C WT) mice were subjected to the ROP model. An increase in total retinal vascularisation was found at p17 owing to endothelial JAM-C deficiency, which was the result of enhanced revascularisation and vessel normalisation, thereby leading to significantly reduced avascular area in EC-JAM-C KO mice. In contrast, pathologic neovessel formation was not affected by endothelial JAM-C deficiency. Consistent with improved vessel normalisation, tip cell formation at the interface between vascular and avascular area was higher in EC-JAM-C KO mice, as compared to their littermate controls. Consistently, JAM-C inactivation in endothelial cells resulted in increased spreading on fibronectin and enhanced sprouting in vitro in a manner dependent on ?1-integrin and on the activation of the small GTPase RAP1. Together, endothelial deletion of JAM-C promoted endothelial cell sprouting, and consequently vessel normalisation and revascularisation of the hypoxic retina without altering pathologic neovascularisation. Thus, targeting endothelial JAM-C may provide a novel therapeutic strategy for promoting revascularisation and vessel normalisation in the treatment of proliferative retinopathies. |
|
Patel A, Lee HO, Jawerth L, Maharana S, Jahnel M, Hein MY, Stoynov S, Mahamid J, Saha S, Franzmann TM, Pozniakovski A, Poser I, Maghelli N, Royer LA, Weigert M, Myers EW, Grill S, Drechsel D, Hyman AA, Alberti S
|
A Liquid-to-Solid Phase Transition of the ALS Protein FUS Accelerated by Disease Mutation.
|
Cell 2015 Aug 27;162(5):1066-77
|
|
Cell Biology
|

|
26317470 |
|
Many proteins contain disordered regions of low-sequence complexity, which cause aging-associated diseases because they are prone to aggregate. Here, we study FUS, a prion-like protein containing intrinsically disordered domains associated with the neurodegenerative disease ALS. We show that, in cells, FUS forms liquid compartments at sites of DNA damage and in the cytoplasm upon stress. We confirm this by reconstituting liquid FUS compartments in vitro. Using an in vitro "aging" experiment, we demonstrate that liquid droplets of FUS protein convert with time from a liquid to an aggregated state, and this conversion is accelerated by patient-derived mutations. We conclude that the physiological role of FUS requires forming dynamic liquid-like compartments. We propose that liquid-like compartments carry the trade-off between functionality and risk of aggregation and that aberrant phase transitions within liquid-like compartments lie at the heart of ALS and, presumably, other age-related diseases. |
|
Wagenführ L, Meyer AK, Braunschweig L, Marrone L, Storch A
|
Brain oxygen tension controls the expansion of outer subventricular zone-like basal progenitors in the developing mouse brain.
|
Development 2015 Sep 1;142(17):2904-15
|
|
Developmental Biology
|

|
26329599 |
Corticogenesis; Gyrencephalic brain; Hypoxia; Lissencephalic brain; Neural stem and progenitor cells; Outer subventricular zone (OSVZ); Oxygen tension |
The mammalian neocortex shows a conserved six-layered structure that differs between species in the total number of cortical neurons produced owing to differences in the relative abundance of distinct progenitor populations. Recent studies have identified a new class of proliferative neurogenic cells in the outer subventricular zone (OSVZ) in gyrencephalic species such as primates and ferrets. Lissencephalic brains of mice possess fewer OSVZ-like progenitor cells and these do not constitute a distinct layer. Most in vitro and in vivo studies have shown that oxygen regulates the maintenance, proliferation and differentiation of neural progenitor cells. Here we dissect the effects of fetal brain oxygen tension on neural progenitor cell activity using a novel mouse model that allows oxygen tension to be controlled within the hypoxic microenvironment in the neurogenic niche of the fetal brain in vivo. Indeed, maternal oxygen treatment of 10%, 21% and 75% atmospheric oxygen tension for 48?h translates into robust changes in fetal brain oxygenation. Increased oxygen tension in fetal mouse forebrain in vivo leads to a marked expansion of a distinct proliferative cell population, basal to the SVZ. These cells constitute a novel neurogenic cell layer, similar to the OSVZ, and contribute to corticogenesis by heading for deeper cortical layers as a part of the cortical plate. |
|
Poser SW, Chenoweth JG, Colantuoni C, Masjkur J, Chrousos G, Bornstein SR, McKay RD, Androutsellis-Theotokis A
|
Concise Review: Reprogramming, Behind the Scenes: Noncanonical Neural Stem Cell Signaling Pathways Reveal New, Unseen Regulators of Tissue Plasticity With Therapeutic Implications.
|
Stem Cells Transl Med 2015 Nov 14;4(11):1251-7
|
|
Neurobiology
|
|
26371344 |
Cellular reprogramming; Cellular transdifferentiation; Hes3 protein; Induced pluripotent stem cells; Pancreatic islets; STAT3 transcription factor; Signal transduction |
Interest is great in the new molecular concepts that explain, at the level of signal transduction, the process of reprogramming. Usually, transcription factors with developmental importance are used, but these approaches give limited information on the signaling networks involved, which could reveal new therapeutic opportunities. Recent findings involving reprogramming by genetic means and soluble factors with well-studied downstream signaling mechanisms, including signal transducer and activator of transcription 3 (STAT3) and hairy and enhancer of split 3 (Hes3), shed new light into the molecular mechanisms that might be involved. We examine the appropriateness of common culture systems and their ability to reveal unusual (noncanonical) signal transduction pathways that actually operate in vivo. We then discuss such novel pathways and their importance in various plastic cell types, culminating in their emerging roles in reprogramming mechanisms. We also discuss a number of reprogramming paradigms (mouse induced pluripotent stem cells, direct conversion to neural stem cells, and in vivo conversion of acinar cells to ?-like cells). Specifically for acinar-to-?-cell reprogramming paradigms, we discuss the common view of the underlying mechanism (involving the Janus kinase-STAT pathway that leads to STAT3-tyrosine phosphorylation) and present alternative interpretations that implicate STAT3-serine phosphorylation alone or serine and tyrosine phosphorylation occurring in sequential order. The implications for drug design and therapy are important given that different phosphorylation sites on STAT3 intercept different signaling pathways. We introduce a new molecular perspective in the field of reprogramming with broad implications in basic, biotechnological, and translational research. |
|
Arai Y, Sampaio JL, Wilsch-Bräuninger M, Ettinger AW, Haffner C, Huttner WB
|
Lipidome of midbody released from neural stem and progenitor cells during mammalian cortical neurogenesis.
|
Front Cell Neurosci 2015 Aug 28;9:325
|
|
Developmental Biology
|

|
26379497 |
mammalian cortical neurogenesis; midbody; neural stem cells; phosphatydylserine; shotgun lipidomic analysis |
Midbody release from proliferative neural progenitor cells is tightly associated with the neuronal commitment of neural progenitor cells during the progression of neurogenesis in the mammalian cerebral cortex. While the central portion of the midbody, a cytoplasmic bridge between nascent daughter cells, is engulfed by one of the daughter cell by most cells in vitro, it is shown to be released into the extracellular cerebrospinal fluid (CF) in vivo in mouse embryos. Several proteins have been involved in midbody release; however, few studies have addressed the participation of the plasma membrane's lipids in this process. Here, we show by Shotgun Lipidomic analysis that phosphatydylserine (PS), among other lipids, is enriched in the released midbodies compared to lipoparticles and cellular membranes, both collected from the CF of the developing mouse embryos. Moreover, the developing mouse embryo neural progenitor cells released two distinct types of midbodies carrying either internalized PS or externalized PS on their membrane. This strongly suggests that phagocytosis and an alternative fate of released midbodies exists. HeLa cells, which are known to mainly engulf the midbody show almost no PS exposure, if any, on the outer leaflet of the midbody membrane. These results point toward that PS exposure might be involved in the selection of recipients of released midbodies, either to be engulfed by daughter cells or phagocytosed by non-daughter cells or another cell type in the developing cerebral cortex. |
|
Dzafic E, Strzyz PJ, Wilsch-Bräuninger M, Norden C
|
Centriole Amplification in Zebrafish Affects Proliferation and Survival but Not Differentiation of Neural Progenitor Cells.
|
Cell Rep 2015 Oct 6;13(1):168-82
|
|
Cell Biology
|

|
26411683 |
|
In animal cells, supernumerary centrosomes, resulting from centriole amplification, cause mitotic aberrations and have been associated with diseases, including microcephaly and cancer. To evaluate how centriole amplification impacts organismal development at the cellular and tissue levels, we used the in vivo imaging potential of the zebrafish. We demonstrate that centriole amplification can induce multipolar anaphase, resulting in binucleated cells. Such binucleation causes substantial apoptosis in the neuroepithelium. Interestingly, not all epithelia are similarly sensitive to binucleation, as skin cells tolerate it without entering apoptosis. In the neuroepithelium, however, binucleation leads to tissue degeneration and subsequent organismal death. Notably, this tissue degeneration can be efficiently counterbalanced by compensatory proliferation of wild-type cells. Because the risk for generating a binucleated daughter recurs at every cell division, centriole amplification in the neuroepithelium is especially deleterious during progenitor proliferation. Once cells reach the differentiation phase, however, centriole amplification does not impair neuronal differentiation. |
|
Ehret F, Vogler S, Kempermann G
|
A co-culture model of the hippocampal neurogenic niche reveals differential effects of astrocytes, endothelial cells and pericytes on proliferation and differentiation of adult murine precursor cells.
|
Stem Cell Res 2015 Nov 26;15(3):514-21
|
|
Neurobiology
|

|
26448270 |
|
The niche concept of stem cell biology proposes a functional unit between the precursor cells and their local microenvironment, to which several cell types might contribute by cell-cell contacts, extracellular matrix, and humoral factors. We here established three co-culture models (with cell types separated by membrane) for both adherent monolayers and neurospheres to address the potential influence of different niche cell types in the neurogenic zone of the adult hippocampus of mice. Astrocytes and endothelial cells enhanced precursor cell proliferation and neurosphere formation. Endothelial factors also led to a prolonged increase in proliferation after growth factor withdrawal, which otherwise induces differentiation. All niche cell types enhanced cell survival in monolayer cultures, endothelial cells also stimulated neuronal differentiation. A parallel trend elicited by astrocytes did not reach conventional statistical significance. Pericytes had variable effects here. We did not observe changes in differentiation in neurosphere co-cultures. In summary, our data indicate that in precursor cell culture protocols survival could be improved by adding as yet unknown factors physiologically contributed by astrocytes and endothelial cells. Our findings also underscore the complexity of the niche and the differential impact of factors from the different sources on distinct aspects of neuronal development. With the help of the models presented here, identification of these factors and their specific biological activity can now be initiated. |
|
Rahman MM, Munzig M, Kaneshiro K, Lee B, Strome S, Müller-Reichert T, Cohen-Fix O
|
Caenorhabditis elegans polo-like kinase PLK-1 is required for merging parental genomes into a single nucleus.
|
Mol. Biol. Cell 2015 Dec 15;26(25):4718-35
|
|
Cell Biology
|

|
26490119 |
|
Before the first zygotic division, the nuclear envelopes of the maternal and paternal pronuclei disassemble, allowing both sets of chromosomes to be incorporated into a single nucleus in daughter cells after mitosis. We found that in Caenorhabditis elegans, partial inactivation of the polo-like kinase PLK-1 causes the formation of two nuclei, containing either the maternal or paternal chromosomes, in each daughter cell. These two nuclei gave rise to paired nuclei in all subsequent cell divisions. The paired-nuclei phenotype was caused by a defect in forming a gap in the nuclear envelopes at the interface between the two pronuclei during the first mitotic division. This was accompanied by defects in chromosome congression and alignment of the maternal and paternal metaphase plates relative to each other. Perturbing chromosome congression by other means also resulted in failure to disassemble the nuclear envelope between the two pronuclei. Our data further show that PLK-1 is needed for nuclear envelope breakdown during early embryogenesis. We propose that during the first zygotic division, PLK-1-dependent chromosome congression and metaphase plate alignment are necessary for the disassembly of the nuclear envelope between the two pronuclei, ultimately allowing intermingling of the maternal and paternal chromosomes. |
|
Reichert D, Friedrichs J, Ritter S, Käubler T, Werner C, Bornhäuser M, Corbeil D
|
Phenotypic, Morphological and Adhesive Differences of Human Hematopoietic Progenitor Cells Cultured on Murine versus Human Mesenchymal Stromal Cells.
|
Sci Rep 2015 Oct 26;5:15680
|
- EMF & Histo CMCB
- LMF CMCB
|
Cell Biology
|

|
26498381 |
|
Xenogenic transplantation models have been developed to study human hematopoiesis in immunocompromised murine recipients. They still have limitations and therefore it is important to delineate all players within the bone marrow that could account for species-specific differences. Here, we evaluated the proliferative capacity, morphological and physical characteristics of human CD34(+) hematopoietic stem and progenitor cells (HSPCs) after co-culture on murine or human bone marrow-derived mesenchymal stromal cells (MSCs). After seven days, human CD34(+)CD133(-) HSPCs expanded to similar extents on both feeder layers while cellular subsets comprising primitive CD34(+)CD133(+) and CD133(+)CD34(-) phenotypes are reduced fivefold on murine MSCs. The number of migrating HSPCs was also reduced on murine cells suggesting that MSC adhesion influences cellular polarization of HSPC. We used atomic force microscopy-based single-cell force spectroscopy to quantify their adhesive interactions. We found threefold higher detachment forces of human HSPCs from murine MSCs compared to human ones. This difference is related to the N-cadherin expression level on murine MSCs since its knockdown abolished their differential adhesion properties with human HSPCs. Our observations highlight phenotypic, morphological and adhesive differences of human HSPCs when cultured on murine or human MSCs, which raise some caution in data interpretation when xenogenic transplantation models are used. |
|
Anastasiou V, Ninou E, Alexopoulou D, Stertmann J, Müller A, Dahl A, Solimena M, Speier S, Serafimidis I, Gavalas A
|
Aldehyde dehydrogenase activity is necessary for beta cell development and functionality in mice.
|
Diabetologia 2016 Jan 31;59(1):139-50
|
- EMF & Histo CMCB
- LMF CMCB
|
Medical Biology
|

|
26518685 |
Aldehyde dehydrogenase; Beta cell development; Beta cell dysfunction; Beta cell transcriptome; Diabetes risk factor; Hyperglycaemia; Insulin secretion |
Pancreatic beta cells maintain glucose homeostasis and beta cell dysfunction is a major risk factor in developing diabetes. Therefore, understanding the developmental regulatory networks that define a fully functional beta cell is important for elucidating the genetic origins of the disease. Aldehyde dehydrogenase activity has been associated with stem/progenitor cells and we have previously shown that Aldh1b1 is specifically expressed in pancreas progenitor pools. Here we address the hypothesis that Aldh1b1 may regulate the timing of the appearance and eventual functionality of beta cells. |
|
Flores-Benitez D, Knust E
|
Crumbs is an essential regulator of cytoskeletal dynamics and cell-cell adhesion during dorsal closure in Drosophila.
|
Elife 2015 Nov 06;4
|
- EMF & Histo CMCB
- LMF MPI-CBG
|
Developmental Biology
|

|
26544546 |
Crumbs; D. melanogaster; actomyosin; amnioserosa; cell adhesion; cell biology; dorsal closure; epithelia |
The evolutionarily conserved Crumbs protein is required for epithelial polarity and morphogenesis. Here we identify a novel role of Crumbs as a negative regulator of actomyosin dynamics during dorsal closure in the Drosophila embryo. Embryos carrying a mutation in the FERM (protein 4.1/ezrin/radixin/moesin) domain-binding motif of Crumbs die due to an overactive actomyosin network associated with disrupted adherens junctions. This phenotype is restricted to the amnioserosa and does not affect other embryonic epithelia. This function of Crumbs requires DMoesin, the Rho1-GTPase, class-I p21-activated kinases and the Arp2/3 complex. Data presented here point to a critical role of Crumbs in regulating actomyosin dynamics, cell junctions and morphogenesis. |
|
Rodrigo Albors A, Tazaki A, Rost F, Nowoshilow S, Chara O, Tanaka EM
|
Planar cell polarity-mediated induction of neural stem cell expansion during axolotl spinal cord regeneration.
|
Elife 2015 Nov 14;4:e10230
|
|
Cell Biology
|

|
26568310 |
axolotl; cell biology; developmental biology; neural stem cells; planar cell polarity; regeneration; spinal cord; stem cells |
Axolotls are uniquely able to mobilize neural stem cells to regenerate all missing regions of the spinal cord. How a neural stem cell under homeostasis converts after injury to a highly regenerative cell remains unknown. Here, we show that during regeneration, axolotl neural stem cells repress neurogenic genes and reactivate a transcriptional program similar to embryonic neuroepithelial cells. This dedifferentiation includes the acquisition of rapid cell cycles, the switch from neurogenic to proliferative divisions, and the re-expression of planar cell polarity (PCP) pathway components. We show that PCP induction is essential to reorient mitotic spindles along the anterior-posterior axis of elongation, and orthogonal to the cell apical-basal axis. Disruption of this property results in premature neurogenesis and halts regeneration. Our findings reveal a key role for PCP in coordinating the morphogenesis of spinal cord outgrowth with the switch from a homeostatic to a regenerative stem cell that restores missing tissue. |
|
García-Martín R, Alexaki VI, Qin N, Rubín de Celis MF, Economopoulou M, Ziogas A, Gercken B, Kotlabova K, Phieler J, Ehrhart-Bornstein M, Bornstein SR, Eisenhofer G, Breier G, Blüher M, Hampe J, El-Armouche A, Chatzigeorgiou A, Chung KJ, Chavakis T
|
Adipocyte-Specific Hypoxia-Inducible Factor 2α Deficiency Exacerbates Obesity-Induced Brown Adipose Tissue Dysfunction and Metabolic Dysregulation.
|
Mol. Cell. Biol. 2016 Feb 16;36(3):376-93
|
|
Medical Biology
|

|
26572826 |
|
Angiogenesis is a central regulator for white (WAT) and brown (BAT) adipose tissue adaptation in the course of obesity. Here we show that deletion of hypoxia-inducible factor 2α (HIF2α) in adipocytes (by using Fabp4-Cre transgenic mice) but not in myeloid or endothelial cells negatively impacted WAT angiogenesis and promoted WAT inflammation, WAT dysfunction, hepatosteatosis, and systemic insulin resistance in obesity. Importantly, adipocyte HIF2α regulated vascular endothelial growth factor (VEGF) expression and angiogenesis of obese BAT as well as its thermogenic function. Consistently, obese adipocyte-specific HIF2α-deficient mice displayed BAT dysregulation, associated with reduced levels of uncoupling protein 1 (UCP1) and a dysfunctional thermogenic response to cold exposure. VEGF administration reversed WAT and BAT inflammation and BAT dysfunction in adipocyte HIF2α-deficient mice. Together, our findings show that adipocyte HIF2α is protective against maladaptation to obesity and metabolic dysregulation by promoting angiogenesis in both WAT and BAT and by counteracting obesity-mediated BAT dysfunction. |
|
Rudolf K, Umetsu D, Aliee M, Sui L, Jülicher F, Dahmann C
|
A local difference in Hedgehog signal transduction increases mechanical cell bond tension and biases cell intercalations along the Drosophila anteroposterior compartment boundary.
|
Development 2015 Nov 15;142(22):3845-58
|
|
Developmental Biology
|

|
26577205 |
Cell sorting; Compartment boundary; Drosophila; Hedgehog; Mechanical tension |
Tissue organization requires the interplay between biochemical signaling and cellular force generation. The formation of straight boundaries separating cells with different fates into compartments is important for growth and patterning during tissue development. In the developing Drosophila wing disc, maintenance of the straight anteroposterior (AP) compartment boundary involves a local increase in mechanical tension at cell bonds along the boundary. The biochemical signals that regulate mechanical tension along the AP boundary, however, remain unknown. Here, we show that a local difference in Hedgehog signal transduction activity between anterior and posterior cells is necessary and sufficient to increase mechanical tension along the AP boundary. This difference in Hedgehog signal transduction is also required to bias cell rearrangements during cell intercalations to keep the characteristic straight shape of the AP boundary. Moreover, severing cell bonds along the AP boundary does not reduce tension at neighboring bonds, implying that active mechanical tension is upregulated, cell bond by cell bond. Finally, differences in the expression of the homeodomain-containing protein Engrailed also contribute to the straight shape of the AP boundary, independently of Hedgehog signal transduction and without modulating cell bond tension. Our data reveal a novel link between local differences in Hedgehog signal transduction and a local increase in active mechanical tension of cell bonds that biases junctional rearrangements. The large-scale shape of the AP boundary thus emerges from biochemical signals inducing patterns of active tension on cell bonds. |
|
Langbein H, Brunssen C, Hofmann A, Cimalla P, Brux M, Bornstein SR, Deussen A, Koch E, Morawietz H
|
NADPH oxidase 4 protects against development of endothelial dysfunction and atherosclerosis in LDL receptor deficient mice.
|
Eur. Heart J. 2016 Jun 7;37(22):1753-61
|
|
Medical Biology
|

|
26578199 |
Atherosclerosis; Endothelial dysfunction; Flow-mediated dilation; Ldlr?/? mice; NADPH oxidase 4; Nox4 |
Endothelial dysfunction is an early step in the development of atherosclerosis. Increased formation of superoxide anions by NADPH oxidase Nox1, 2, and 5 reduces nitric oxide availability and can promote endothelial dysfunction. In contrast, recent evidence supports a vasoprotective role of H2O2 produced by main endothelial isoform Nox4. Therefore, we analysed the impact of genetic deletion of Nox4 on endothelial dysfunction and atherosclerosis in the low-density lipoprotein receptor (Ldlr) knockout model. |
|
Fauser M, Löhle M, Ebersbach G, Odin P, Fuchs G, Jost WH, Chaudhuri KR, Koch R, , Storch A
|
Intraindividual Variability of Nonmotor Fluctuations in Advanced Parkinson's Disease.
|
J Parkinsons Dis 2015;5(4):737-41
|
|
Neurobiology
|
|
26639660 |
NMS domains; Nonmotor symptoms; Parkinson’s disease; intraindividual variability; nonmotor fluctuations |
Nonmotor symptoms (NMS) fluctuate in conjunction with motor oscillations in advanced Parkinson's disease (PD), though little is known about the variability of NMS fluctuations in individual patients. We aimed to assess within-patient variability in frequency and severity of NMS during a series of five patient-perceived motor On and Off periods in 38 fluctuating PD patients from the multicenter NonMotorFluctuations in PD study using a visual analogue scale. NMS frequency and severity appeared moderately variable in both motor states within individual patients. Symptom severity ranges between motor states showed high variability and were larger in motor Off states for most NMS. |
|
Camp JG, Badsha F, Florio M, Kanton S, Gerber T, Wilsch-Bräuninger M, Lewitus E, Sykes A, Hevers W, Lancaster M, Knoblich JA, Lachmann R, Pääbo S, Huttner WB, Treutlein B
|
Human cerebral organoids recapitulate gene expression programs of fetal neocortex development.
|
Proc. Natl. Acad. Sci. U.S.A. 2015 Dec 22;112(51):15672-7
|
|
Cell Biology
|

|
26644564 |
cerebral organoid; corticogenesis; neocortex; single-cell RNA-seq; stem cells |
Cerebral organoids-3D cultures of human cerebral tissue derived from pluripotent stem cells-have emerged as models of human cortical development. However, the extent to which in vitro organoid systems recapitulate neural progenitor cell proliferation and neuronal differentiation programs observed in vivo remains unclear. Here we use single-cell RNA sequencing (scRNA-seq) to dissect and compare cell composition and progenitor-to-neuron lineage relationships in human cerebral organoids and fetal neocortex. Covariation network analysis using the fetal neocortex data reveals known and previously unidentified interactions among genes central to neural progenitor proliferation and neuronal differentiation. In the organoid, we detect diverse progenitors and differentiated cell types of neuronal and mesenchymal lineages and identify cells that derived from regions resembling the fetal neocortex. We find that these organoid cortical cells use gene expression programs remarkably similar to those of the fetal tissue to organize into cerebral cortex-like regions. Our comparison of in vivo and in vitro cortical single-cell transcriptomes illuminates the genetic features underlying human cortical development that can be studied in organoid cultures. |
|
Morales-Navarrete H, Segovia-Miranda F, Klukowski P, Meyer K, Nonaka H, Marsico G, Chernykh M, Kalaidzidis A, Zerial M, Kalaidzidis Y
|
A versatile pipeline for the multi-scale digital reconstruction and quantitative analysis of 3D tissue architecture.
|
Elife 2015 Dec 27;4
|
|
Image Processing
|

|
26673893 |
3D tissue geometrical model; computational biology; developmental biology; image analysis; mouse; stem cells; systems biology |
A prerequisite for the systems biology analysis of tissues is an accurate digital three-dimensional reconstruction of tissue structure based on images of markers covering multiple scales. Here, we designed a flexible pipeline for the multi-scale reconstruction and quantitative morphological analysis of tissue architecture from microscopy images. Our pipeline includes newly developed algorithms that address specific challenges of thick dense tissue reconstruction. Our implementation allows for a flexible workflow, scalable to high-throughput analysis and applicable to various mammalian tissues. We applied it to the analysis of liver tissue and extracted quantitative parameters of sinusoids, bile canaliculi and cell shapes, recognizing different liver cell types with high accuracy. Using our platform, we uncovered an unexpected zonation pattern of hepatocytes with different size, nuclei and DNA content, thus revealing new features of liver tissue organization. The pipeline also proved effective to analyse lung and kidney tissue, demonstrating its generality and robustness. |
|
Stapel LC, Lombardot B, Broaddus C, Kainmueller D, Jug F, Myers EW, Vastenhouw NL
|
Automated detection and quantification of single RNAs at cellular resolution in zebrafish embryos.
|
Development 2016 Feb 1;143(3):540-6
|
|
Image Processing
|

|
26700682 |
Cell segmentation; Gene expression; Image analysis pipeline; Zebrafish; smFISH |
Analysis of differential gene expression is crucial for the study of cell fate and behavior during embryonic development. However, automated methods for the sensitive detection and quantification of RNAs at cellular resolution in embryos are lacking. With the advent of single-molecule fluorescence in situ hybridization (smFISH), gene expression can be analyzed at single-molecule resolution. However, the limited availability of protocols for smFISH in embryos and the lack of efficient image analysis pipelines have hampered quantification at the (sub)cellular level in complex samples such as tissues and embryos. Here, we present a protocol for smFISH on zebrafish embryo sections in combination with an image analysis pipeline for automated transcript detection and cell segmentation. We use this strategy to quantify gene expression differences between different cell types and identify differences in subcellular transcript localization between genes. The combination of our smFISH protocol and custom-made, freely available, analysis pipeline will enable researchers to fully exploit the benefits of quantitative transcript analysis at cellular and subcellular resolution in tissues and embryos. |
|
Kotzsch A, Pawolski D, Milentyev A, Shevchenko A, Scheffel A, Poulsen N, Shevchenko A, Kröger N
|
Biochemical Composition and Assembly of Biosilica-associated Insoluble Organic Matrices from the Diatom Thalassiosira pseudonana.
|
J. Biol. Chem. 2016 Mar 4;291(10):4982-97
|
- EMF & Histo CMCB
- LMF CMCB
|
Cell Biology
|

|
26710847 |
algae; biomineralization; cell wall; intrinsically disordered protein; morphogenesis; post-translational modification (PTM); protein self-assembly; proteomics |
The nano- and micropatterned biosilica cell walls of diatoms are remarkable examples of biological morphogenesis and possess highly interesting material properties. Only recently has it been demonstrated that biosilica-associated organic structures with specific nanopatterns (termed insoluble organic matrices) are general components of diatom biosilica. The model diatom Thalassiosira pseudonana contains three types of insoluble organic matrices: chitin meshworks, organic microrings, and organic microplates, the latter being described in the present study for the first time. To date, little is known about the molecular composition, intracellular assembly, and biological functions of organic matrices. Here we have performed structural and functional analyses of the organic microrings and organic microplates from T. pseudonana. Proteomics analysis yielded seven proteins of unknown function (termed SiMat proteins) together with five known silica biomineralization proteins (four cingulins and one silaffin). The location of SiMat1-GFP in the insoluble organic microrings and the similarity of tyrosine- and lysine-rich functional domains identifies this protein as a new member of the cingulin protein family. Mass spectrometric analysis indicates that most of the lysine residues of cingulins and the other insoluble organic matrix proteins are post-translationally modified by short polyamine groups, which are known to enhance the silica formation activity of proteins. Studies with recombinant cingulins (rCinY2 and rCinW2) demonstrate that acidic conditions (pH 5.5) trigger the assembly of mixed cingulin aggregates that have silica formation activity. Our results suggest an important role for cingulins in the biogenesis of organic microrings and support the hypothesis that this type of insoluble organic matrix functions in biosilica morphogenesis. |
|
Kajtez J, Solomatina A, Novak M, Polak B, Vukušić K, Rüdiger J, Cojoc G, Milas A, Šumanovac Šestak I, Risteski P, Tavano F, Klemm AH, Roscioli E, Welburn J, Cimini D, Glunčić M, Pavin N, Tolić IM
|
Overlap microtubules link sister k-fibres and balance the forces on bi-oriented kinetochores.
|
Nat Commun 2016 Jan 05;7:10298
|
|
Biophysics
|

|
26728792 |
|
During metaphase, forces on kinetochores are exerted by k-fibres, bundles of microtubules that end at the kinetochore. Interestingly, non-kinetochore microtubules have been observed between sister kinetochores, but their function is unknown. Here we show by laser-cutting of a k-fibre in HeLa and PtK1 cells that a bundle of non-kinetochore microtubules, which we term 'bridging fibre', bridges sister k-fibres and balances the interkinetochore tension. We found PRC1 and EB3 in the bridging fibre, suggesting that it consists of antiparallel dynamic microtubules. By using a theoretical model that includes a bridging fibre, we show that the forces at the pole and at the kinetochore depend on the bridging fibre thickness. Moreover, our theory and experiments show larger relaxation of the interkinetochore distance for cuts closer to kinetochores. We conclude that the bridging fibre, by linking sister k-fibres, withstands the tension between sister kinetochores and enables the spindle to obtain a curved shape. |
|
Radin I, Mansilla N, Rödel G, Steinebrunner I
|
The Arabidopsis COX11 Homolog is Essential for Cytochrome c Oxidase Activity.
|
Front Plant Sci 2015 Dec 18;6:1091
|
|
Cell Biology
|

|
26734017 |
Arabidopsis thaliana; COX complex; COX11 (cytochrome c oxidase 11); copper chaperone; mitochondria; pollen development; root development |
Members of the ubiquitous COX11 (cytochrome c oxidase 11) protein family are involved in copper delivery to the COX complex. In this work, we characterize the Arabidopsis thaliana COX11 homolog (encoded by locus At1g02410). Western blot analyses and confocal microscopy identified Arabidopsis COX11 as an integral mitochondrial protein. Despite sharing high sequence and structural similarities, the Arabidopsis COX11 is not able to functionally replace the Saccharomyces cerevisiae COX11 homolog. Nevertheless, further analysis confirmed the hypothesis that Arabidopsis COX11 is essential for COX activity. Disturbance of COX11 expression through knockdown (KD) or overexpression (OE) affected COX activity. In KD lines, the activity was reduced by ~50%, resulting in root growth inhibition, smaller rosettes and leaf curling. In OE lines, the reduction was less pronounced (~80% of the wild type), still resulting in root growth inhibition. Additionally, pollen germination was impaired in COX11 KD and OE plants. This effect on pollen germination can only partially be attributed to COX deficiency and may indicate a possible auxiliary role of COX11 in ROS metabolism. In agreement with its role in energy production, the COX11 promoter is highly active in cells and tissues with high-energy demand for example shoot and root meristems, or vascular tissues of source and sink organs. In COX11 KD lines, the expression of the plasma-membrane copper transporter COPT2 and of several copper chaperones was altered, indicative of a retrograde signaling pathway pertinent to copper homeostasis. Based on our data, we postulate that COX11 is a mitochondrial chaperone, which plays an important role for plant growth and pollen germination as an essential COX complex assembly factor. |
|
Cojoc G, Florescu AM, Krull A, Klemm AH, Pavin N, Jülicher F, Tolić IM
|
Paired arrangement of kinetochores together with microtubule pivoting and dynamics drive kinetochore capture in meiosis I.
|
Sci Rep 2016 May 11;6:25736
|
|
Biophysics
|

|
27166749 |
|
Kinetochores are protein complexes on the chromosomes, whose function as linkers between spindle microtubules and chromosomes is crucial for proper cell division. The mechanisms that facilitate kinetochore capture by microtubules are still unclear. In the present study, we combine experiments and theory to explore the mechanisms of kinetochore capture at the onset of meiosis I in fission yeast. We show that kinetochores on homologous chromosomes move together, microtubules are dynamic and pivot around the spindle pole, and the average capture time is 3-4?minutes. Our theory describes paired kinetochores on homologous chromosomes as a single object, as well as angular movement of microtubules and their dynamics. For the experimentally measured parameters, the model reproduces the measured capture kinetics and shows that the paired configuration of kinetochores accelerates capture, whereas microtubule pivoting and dynamics have a smaller contribution. Kinetochore pairing may be a general feature that increases capture efficiency in meiotic cells. |
|
Currie JD, Kawaguchi A, Traspas RM, Schuez M, Chara O, Tanaka EM
|
Live Imaging of Axolotl Digit Regeneration Reveals Spatiotemporal Choreography of Diverse Connective Tissue Progenitor Pools.
|
Dev Cell. 2016 Nov 21;39(4):411-423
|
|
Cell Biology
|

|
27840105 |
PDGF signaling; axolotl; blastema formation; brainbow; cell migration; connective tissue; limb regeneration; live imaging; skeletal regeneration |
Connective tissues-skeleton, dermis, pericytes, fascia-are a key cell source for regenerating the patterned skeleton during axolotl appendage regeneration. This complexity has made it difficult to identify the cells that regenerate skeletal tissue. Inability to identify these cells has impeded a mechanistic understanding of blastema formation. By tracing cells during digit tip regeneration using brainbow transgenic axolotls, we show that cells from each connective tissue compartment have distinct spatial and temporal profiles of proliferation, migration, and differentiation. Chondrocytes proliferate but do not migrate into the regenerate. In contrast, pericytes proliferate, then migrate into the blastema and give rise solely to pericytes. Periskeletal cells and fibroblasts contribute the bulk of digit blastema cells and acquire diverse fates according to successive waves of migration that choreograph their proximal-distal and tissue contributions. We further show that platelet-derived growth factor signaling is a potent inducer of fibroblast migration, which is required to form the blastema. |
|
Munder MC, Midtvedt D, Franzmann T, Nüske E, Otto O, Herbig M, Ulbricht E, Müller P, Taubenberger A, Maharana S, Malinovska L, Richter D, Guck J, Zaburdaev V, Alberti S
|
A pH-driven transition of the cytoplasm from a fluid- to a solid-like state promotes entry into dormancy.
|
Elife. 2016 Mar 22;5
|
|
Cell Biology
|

|
27003292 |
s. cerevisiae; s. pombe; biophysics; cell biology; cytosolic pH; dictyostelium; dormancy; macromolecular assembly; metabolism; phase transition; starvation; structural biology |
Cells can enter into a dormant state when faced with unfavorable conditions. However, how cells enter into and recover from this state is still poorly understood. Here, we study dormancy in different eukaryotic organisms and find it to be associated with a significant decrease in the mobility of organelles and foreign tracer particles. We show that this reduced mobility is caused by an influx of protons and a marked acidification of the cytoplasm, which leads to widespread macromolecular assembly of proteins and triggers a transition of the cytoplasm to a solid-like state with increased mechanical stability. We further demonstrate that this transition is required for cellular survival under conditions of starvation. Our findings have broad implications for understanding alternative physiological states, such as quiescence and dormancy, and create a new view of the cytoplasm as an adaptable fluid that can reversibly transition into a protective solid-like state. |
|
Boke E, Ruer M, Wühr M, Coughlin M, Lemaitre R, Gygi SP, Alberti S, Drechsel D, Hyman AA, Mitchison TJ
|
Amyloid-like Self-Assembly of a Cellular Compartment.
|
Cell. 2016 Jul 28;166(3):637-650
|
|
Cell Biology
|

|
27471966 |
velo1 |
Most vertebrate oocytes contain a Balbiani body, a large, non-membrane-bound compartment packed with RNA, mitochondria, and other organelles. Little is known about this compartment, though it specifies germline identity in many non-mammalian vertebrates. We show Xvelo, a disordered protein with an N-terminal prion-like domain, is an abundant constituent of Xenopus Balbiani bodies. Disruption of the prion-like domain of Xvelo, or substitution with a prion-like domain from an unrelated protein, interferes with its incorporation into Balbiani bodies in vivo. Recombinant Xvelo forms amyloid-like networks in vitro. Amyloid-like assemblies of Xvelo recruit both RNA and mitochondria in binding assays. We propose that Xenopus Balbiani bodies form by amyloid-like assembly of Xvelo, accompanied by co-recruitment of mitochondria and RNA. Prion-like domains are found in germ plasm organizing proteins in other species, suggesting that Balbiani body formation by amyloid-like assembly could be a conserved mechanism that helps oocytes function as long-lived germ cells. |
|
Stepanek L, Pigino G
|
Microtubule doublets are double-track railways for intraflagellar transport trains.
|
Science. 2016 May 6;352(6286):721-4
|
|
Imaging Technologies Development
|

|
27151870 |
|
The cilium is a large macromolecular machine that is vital for motility, signaling, and sensing in most eukaryotic cells. Its conserved core structure, the axoneme, contains nine microtubule doublets, each comprising a full A-microtubule and an incomplete B-microtubule. However, thus far, the function of this doublet geometry has not been understood. We developed a time-resolved correlative fluorescence and three-dimensional electron microscopy approach to investigate the dynamics of intraflagellar transport (IFT) trains, which carry ciliary building blocks along microtubules during the assembly and disassembly of the cilium. Using this method, we showed that each microtubule doublet is used as a bidirectional double-track railway: Anterograde IFT trains move along B-microtubules, and retrograde trains move along A-microtubules. Thus, the microtubule doublet geometry provides direction-specific rails to coordinate bidirectional transport of ciliary components. |
|
Schmied C, Steinbach P, Pietzsch T, Preibisch S, Tomancak P
|
An automated workflow for parallel processing of large multiview SPIM recordings.
|
Bioinformatics. 2016 Apr 1;32(7):1112-4
|
|
Image Processing
|

|
26628585 |
|
Selective Plane Illumination Microscopy (SPIM) allows to image developing organisms in 3D at unprecedented temporal resolution over long periods of time. The resulting massive amounts of raw image data requires extensive processing interactively via dedicated graphical user interface (GUI) applications. The consecutive processing steps can be easily automated and the individual time points can be processed independently, which lends itself to trivial parallelization on a high performance computing (HPC) cluster. Here, we introduce an automated workflow for processing large multiview, multichannel, multiillumination time-lapse SPIM data on a single workstation or in parallel on a HPC cluster. The pipeline relies on snakemake to resolve dependencies among consecutive processing steps and can be easily adapted to any cluster environment for processing SPIM data in a fraction of the time required to collect it. |
|
Sarov M, Barz C, Jambor H, Hein MY, Schmied C, Suchold D, Stender B, Janosch S, K J VV, Krishnan RT, Krishnamoorthy A, Ferreira IR, Ejsmont RK, Finkl K, Hasse S, Kämpfer P, Plewka N, Vinis E, Schloissnig S, Knust E, Hartenstein V, Mann M, Ramaswami M, VijayRaghavan K, Tomancak P, Schnorrer F
|
A genome-wide resource for the analysis of protein localisation in Drosophila.
|
Elife. 2016 Feb 20;5:e12068
|
|
Developmental Biology
|

|
26896675 |
d. melanogaster; developmental biology; drosophila; evolutionary biology; genetics; genomics; live imaging; protein tagging; recombineering; resource; stem cells |
The Drosophila genome contains >13000 protein-coding genes, the majority of which remain poorly investigated. Important reasons include the lack of antibodies or reporter constructs to visualise these proteins. Here, we present a genome-wide fosmid library of 10000 GFP-tagged clones, comprising tagged genes and most of their regulatory information. For 880 tagged proteins, we created transgenic lines, and for a total of 207 lines, we assessed protein expression and localisation in ovaries, embryos, pupae or adults by stainings and live imaging approaches. Importantly, we visualised many proteins at endogenous expression levels and found a large fraction of them localising to subcellular compartments. By applying genetic complementation tests, we estimate that about two-thirds of the tagged proteins are functional. Moreover, these tagged proteins enable interaction proteomics from developing pupae and adult flies. Taken together, this resource will boost systematic analysis of protein expression and localisation in various cellular and developmental contexts. |
|
Saha S, Weber CA, Nousch M, Adame-Arana O, Hoege C, Hein MY, Osborne-Nishimura E, Mahamid J, Jahnel M, Jawerth L, Pozniakovski A, Eckmann CR, Jülicher F, Hyman AA
|
Polar Positioning of Phase-Separated Liquid Compartments in Cells Regulated by an mRNA Competition Mechanism.
|
Cell. 2016 Sep 8;166(6):1572-1584.e16
|
|
Developmental Biology
|

|
27594427 |
|
P granules are non-membrane-bound RNA-protein compartments that are involved in germline development in C. elegans. They are liquids that condense at one end of the embryo by localized phase separation, driven by gradients of polarity proteins such as the mRNA-binding protein MEX-5. To probe how polarity proteins regulate phase separation, we combined biochemistry and theoretical modeling. We reconstitute P granule-like droplets in vitro using a single protein PGL-3. By combining in vitro reconstitution with measurements of intracellular concentrations, we show that competition between PGL-3 and MEX-5 for mRNA can regulate the formation of PGL-3 droplets. Using theory, we show that, in a MEX-5 gradient, this mRNA competition mechanism can drive a gradient of P granule assembly with similar spatial and temporal characteristics to P granule assembly in vivo. We conclude that gradients of polarity proteins can position RNP granules during development by using RNA competition to regulate local phase separation. |
|
Rajasekaran B, Uriu K, Valentin G, Tinevez JY, Oates AC
|
NCBINCBI Logo Skip to main content Skip to navigation Resources How To About NCBI Accesskeys Sign in to NCBI PubMed US National Library of Medicine National Institutes of Health Search database Search term Clear input Create
|
PLoS One. 2016 Jun 22;11(6):e0150853
|
|
Image Processing
|

|
27332860 |
|
Many questions in developmental biology depend on measuring the position and movement of individual cells within developing embryos. Yet, tools that provide this data are often challenged by high cell density and their accuracy is difficult to measure. Here, we present a three-step procedure to address this problem. Step one is a novel segmentation algorithm based on image derivatives that, in combination with selective post-processing, reliably and automatically segments cell nuclei from images of densely packed tissue. Step two is a quantitative validation using synthetic images to ascertain the efficiency of the algorithm with respect to signal-to-noise ratio and object density. Finally, we propose an original method to generate reliable and experimentally faithful ground truth datasets: Sparse-dense dual-labeled embryo chimeras are used to unambiguously measure segmentation errors within experimental data. Together, the three steps outlined here establish a robust, iterative procedure to fine-tune image analysis algorithms and microscopy settings associated with embryonic 3D image data sets. |
|
Nemetschke L, Knust E
|
Drosophila Crumbs prevents ectopic Notch activation in developing wings by inhibiting ligand-independent endocytosis.
|
Development. 2016 Dec 1;143(23):4543-4553
|
|
Developmental Biology
|

|
27899511 |
Crb–Notch interaction; Deltex; Ligand-independent Notch pathway; Wing vein refinement |
Many signalling components are apically restricted in epithelial cells, and receptor localisation and abundance is key for morphogenesis and tissue homeostasis. Hence, controlling apicobasal epithelial polarity is crucial for proper signalling. Notch is a ubiquitously expressed, apically localised receptor, which performs a plethora of functions; therefore, its activity has to be tightly regulated. Here, we show that Drosophila Crumbs, an evolutionarily conserved polarity determinant, prevents Notch endocytosis in developing wings through direct interaction between the two proteins. Notch endocytosis in the absence of Crumbs results in the activation of the ligand-independent, Deltex-dependent Notch signalling pathway, and does not require the ligands Delta and Serrate or ?-secretase activity. This function of Crumbs is not due to general defects in apicobasal polarity, as localisation of other apical proteins is unaffected. Our data reveal a mechanism to explain how Crumbs directly controls localisation and trafficking of the potent Notch receptor, and adds yet another aspect of Crumbs regulation in Notch pathway activity. Furthermore, our data highlight a close link between the apical determinant Crumbs, receptor trafficking and tissue homeostasis. |
|
Mylenko M, Boland S, Penkov S, Sampaio JL, Lombardot B, Vorkel D, Verbavatz JM, Kurzchalia TV
|
NAD+ Is a Food Component That Promotes Exit from Dauer Diapause in Caenorhabditis elegans.
|
PLoS One. 2016 Dec 1;11(12):e0167208
|
- LMF MPI-CBG
- EMF MPI-CBG
- IPF MPI-CBG
|
Cell Biology
|

|
27907064 |
|
The free-living soil nematode Caenorhabditis elegans adapts its development to the availability of food. When food is scarce and population density is high, worms enter a developmentally arrested non-feeding diapause stage specialized for long-term survival called the dauer larva. When food becomes available, they exit from the dauer stage, resume growth and reproduction. It has been postulated that compound(s) present in food, referred to as the "food signal", promote exit from the dauer stage. In this study, we have identified NAD+ as a component of bacterial extract that promotes dauer exit. NAD+, when dissolved in alkaline medium, causes opening of the mouth and ingestion of food. We also show that to initiate exit from the dauer stage in response to NAD+ worms require production of serotonin. Thus, C. elegans can use redox cofactors produced by dietary organisms to sense food. |
|
Mora-Bermúdez F, Badsha F, Kanton S, Camp JG, Vernot B, Köhler K, Voigt B, Okita K, Maricic T, He Z, Lachmann R, Pääbo S, Treutlein B, Huttner WB
|
Differences and similarities between human and chimpanzee neural progenitors during cerebral cortex development.
|
Elife. 2016 Sep 26;5. pii: e18683
|
|
Neurobiology
|

|
27669147 |
cell biology; cell division; cerebral organoids; chimpanzee; cortical development; developmental biology; human; mouse; neural stem and progenitor cells; single-cell RNA-seq; stem cells |
Human neocortex expansion likely contributed to the remarkable cognitive abilities of humans. This expansion is thought to primarily reflect differences in proliferation versus differentiation of neural progenitors during cortical development. Here, we have searched for such differences by analysing cerebral organoids from human and chimpanzees using immunohistofluorescence, live imaging, and single-cell transcriptomics. We find that the cytoarchitecture, cell type composition, and neurogenic gene expression programs of humans and chimpanzees are remarkably similar. Notably, however, live imaging of apical progenitor mitosis uncovered a lengthening of prometaphase-metaphase in humans compared to chimpanzees that is specific to proliferating progenitors and not observed in non-neural cells. Consistent with this, the small set of genes more highly expressed in human apical progenitors points to increased proliferative capacity, and the proportion of neurogenic basal progenitors is lower in humans. These subtle differences in cortical progenitors between humans and chimpanzees may have consequences for human neocortex evolution. |
|
Lange C, Turrero Garcia M, Decimo I, Bifari F, Eelen G, Quaegebeur A, Boon R, Zhao H, Boeckx B, Chang J, Wu C, Le Noble F, Lambrechts D, Dewerchin M, Kuo CJ, Huttner WB, Carmeliet P
|
Relief of hypoxia by angiogenesis promotes neural stem cell differentiation by targeting glycolysis.
|
EMBO J. 2016 May 2;35(9):924-41
|
|
Neurobiology
|

|
26856890 |
hypoxia; neural stem cell; neurogenesis; stem cell metabolism; vascular niche |
Blood vessels are part of the stem cell niche in the developing cerebral cortex, but their in vivo role in controlling the expansion and differentiation of neural stem cells (NSCs) in development has not been studied. Here, we report that relief of hypoxia in the developing cerebral cortex by ingrowth of blood vessels temporo-spatially coincided with NSC differentiation. Selective perturbation of brain angiogenesis in vessel-specific Gpr124 null embryos, which prevented the relief from hypoxia, increased NSC expansion at the expense of differentiation. Conversely, exposure to increased oxygen levels rescued NSC differentiation in Gpr124 null embryos and increased it further in WT embryos, suggesting that niche blood vessels regulate NSC differentiation at least in part by providing oxygen. Consistent herewith, hypoxia-inducible factor (HIF)-1? levels controlled the switch of NSC expansion to differentiation. Finally, we provide evidence that high glycolytic activity of NSCs is required to prevent their precocious differentiation in vivo Thus, blood vessel function is required for efficient NSC differentiation in the developing cerebral cortex by providing oxygen and possibly regulating NSC metabolism |
|
Kalebic N, Taverna E, Tavano S, Wong FK, Suchold D, Winkler S, Huttner WB, Sarov M
|
CRISPR/Cas9-induced disruption of gene expression in mouse embryonic brain and single neural stem cells in vivo.
|
EMBO Rep. 2016 Mar;17(3):338-48
|
|
Neurobiology
|

|
26758805 |
CRISPR/Cas9; in utero electroporation; microinjection; neural stem cell; neurogenesis |
We have applied the CRISPR/Cas9 system in vivo to disrupt gene expression in neural stem cells in the developing mammalian brain. Two days after in utero electroporation of a single plasmid encoding Cas9 and an appropriate guide RNA (gRNA) into the embryonic neocortex of Tis21::GFP knock-in mice, expression of GFP, which occurs specifically in neural stem cells committed to neurogenesis, was found to be nearly completely (? 90%) abolished in the progeny of the targeted cells. Importantly, upon in utero electroporation directly of recombinant Cas9/gRNA complex, near-maximal efficiency of disruption of GFP expression was achieved already after 24 h. Furthermore, by using microinjection of the Cas9 protein/gRNA complex into neural stem cells in organotypic slice culture, we obtained disruption of GFP expression within a single cell cycle. Finally, we used either Cas9 plasmid in utero electroporation or Cas9 protein complex microinjection to disrupt the expression of Eomes/Tbr2, a gene fundamental for neocortical neurogenesis. This resulted in a reduction in basal progenitors and an increase in neuronal differentiation. Thus, the present in vivo application of the CRISPR/Cas9 system in neural stem cells provides a rapid, efficient and enduring disruption of expression of specific genes to dissect their role in mammalian brain development. |
|
Jahr W, Schmid B, Weber M, Huisken J
|
eduSPIM: Light Sheet Microscopy in the Museum.
|
PLoS One. 2016 Aug 25;11(8):e0161402
|
|
Imaging Technologies Development
|

|
27560188 |
|
LIGHT SHEET MICROSCOPY IN THE MUSEUM:
Light sheet microscopy (or selective plane illumination microscopy) is an important imaging technique in the life sciences. At the same time, this technique is also ideally suited for community outreach projects, because it produces visually appealing, highly dynamic images of living organisms and its working principle can be understood with basic optics knowledge. Still, the underlying concepts are widely unknown to the non-scientific public. On the occasion of the UNESCO International Year of Light, a technical museum in Dresden, Germany, launched a special, interactive exhibition. We built a fully functional, educational selective plane illumination microscope (eduSPIM) to demonstrate how developments in microscopy promote discoveries in biology.
DESIGN PRINCIPLES OF AN EDUCATIONAL LIGHT SHEET MICROSCOPE:
To maximize educational impact, we radically reduced a standard light sheet microscope to its essential components without compromising functionality and incorporated stringent safety concepts beyond those needed in the lab. Our eduSPIM system features one illumination and one detection path and a sealed sample chamber. We image fixed zebrafish embryos with fluorescent vasculature, because the structure is meaningful to laymen and visualises the optical principles of light sheet microscopy. Via a simplified interface, visitors acquire fluorescence and transmission data simultaneously.
THE EDUSPIM DESIGN IS TAILORED EASILY TO FIT NUMEROUS APPLICATIONS:
The universal concepts presented here may also apply to other scientific approaches that are communicated to laymen in interactive settings. The specific eduSPIM design is adapted easily for various outreach and teaching activities. eduSPIM may even prove useful for labs needing a simple SPIM. A detailed parts list and schematics to rebuild eduSPIM are provided. |
|
Icha J, Schmied C, Sidhaye J, Tomancak P, Preibisch S, Norden C
|
Using Light Sheet Fluorescence Microscopy to Image Zebrafish Eye Development.
|
J Vis Exp. 2016 Apr 10;(110):e53966
|
|
Image Processing
|

|
27167079 |
|
Light sheet fluorescence microscopy (LSFM) is gaining more and more popularity as a method to image embryonic development. The main advantages of LSFM compared to confocal systems are its low phototoxicity, gentle mounting strategies, fast acquisition with high signal to noise ratio and the possibility of imaging samples from various angles (views) for long periods of time. Imaging from multiple views unleashes the full potential of LSFM, but at the same time it can create terabyte-sized datasets. Processing such datasets is the biggest challenge of using LSFM. In this protocol we outline some solutions to this problem. Until recently, LSFM was mostly performed in laboratories that had the expertise to build and operate their own light sheet microscopes. However, in the last three years several commercial implementations of LSFM became available, which are multipurpose and easy to use for any developmental biologist. This article is primarily directed to those researchers, who are not LSFM technology developers, but want to employ LSFM as a tool to answer specific developmental biology questions. Here, we use imaging of zebrafish eye development as an example to introduce the reader to LSFM technology and we demonstrate applications of LSFM across multiple spatial and temporal scales. This article describes a complete experimental protocol starting with the mounting of zebrafish embryos for LSFM. We then outline the options for imaging using the commercially available light sheet microscope. Importantly, we also explain a pipeline for subsequent registration and fusion of multiview datasets using an open source solution implemented as a Fiji plugin. While this protocol focuses on imaging the developing zebrafish eye and processing data from a particular imaging setup, most of the insights and troubleshooting suggestions presented here are of general use and the protocol can be adapted to a variety of light sheet microscopy experiments. |
|
Icha J, Kunath C, Rocha-Martins M, Norden C
|
Independent modes of ganglion cell translocation ensure correct lamination of the zebrafish retina.
|
J Cell Biol. 2016 Oct 24;215(2):259-275
|
|
Developmental Biology
|

|
27810916 |
|
The arrangement of neurons into distinct layers is critical for neuronal connectivity and function. During development, most neurons move from their birthplace to the appropriate layer, where they polarize. However, kinetics and modes of many neuronal translocation events still await exploration. In this study, we investigate retinal ganglion cell (RGC) translocation across the embryonic zebrafish retina. After completing their translocation, RGCs establish the most basal retinal layer where they form the optic nerve. Using in toto light sheet microscopy, we show that somal translocation of RGCs is a fast and directed event. It depends on basal process attachment and stabilized microtubules. Interestingly, interference with somal translocation induces a switch to multipolar migration. This multipolar mode is less efficient but still leads to successful RGC layer formation. When both modes are inhibited though, RGCs fail to translocate and induce lamination defects. This indicates that correct RGC translocation is crucial for subsequent retinal lamination. |
|
Murray DH, Jahnel M, Lauer J, Avellaneda MJ, Brouilly N, Cezanne A, Morales-Navarrete H, Perini ED, Ferguson C, Lupas AN, Kalaidzidis Y, Parton RG, Grill SW, Zerial M
|
An endosomal tether undergoes an entropic collapse to bring vesicles together.
|
Nature. 2016 Sep 1;537(7618):107-111
|
- LMF MPI-CBG
- Screening MPI-CBG
|
Cell Biology
|

|
27556945 |
|
An early step in intracellular transport is the selective recognition of a vesicle by its appropriate target membrane, a process regulated by Rab GTPases via the recruitment of tethering effectors. Membrane tethering confers higher selectivity and efficiency to membrane fusion than the pairing of SNAREs (soluble N-ethylmaleimide-sensitive factor attachment protein receptors) alone. Here we address the mechanism whereby a tethered vesicle comes closer towards its target membrane for fusion by reconstituting an endosomal asymmetric tethering machinery consisting of the dimeric coiled-coil protein EEA1 (refs 6, 7) recruited to phosphatidylinositol 3-phosphate membranes and binding vesicles harbouring Rab5. Surprisingly, structural analysis reveals that Rab5:GTP induces an allosteric conformational change in EEA1, from extended to flexible and collapsed. Through dynamic analysis by optical tweezers, we confirm that EEA1 captures a vesicle at a distance corresponding to its extended conformation, and directly measure its flexibility and the forces induced during the tethering reaction. Expression of engineered EEA1 variants defective in the conformational change induce prominent clusters of tethered vesicles in vivo. Our results suggest a new mechanism in which Rab5 induces a change in flexibility of EEA1, generating an entropic collapse force that pulls the captured vesicle towards the target membrane to initiate docking and fusion. |
|
Wueseke O, Zwicker D, Schwager A, Wong YL, Oegema K, Jülicher F, Hyman AA, Woodruff JB
|
Polo-like kinase phosphorylation determines Caenorhabditis elegans centrosome size and density by biasing SPD-5 toward an assembly-competent conformation.
|
Biol Open. 2016 Oct 15;5(10):1431-1440
|
|
Cell Biology
|

|
27591191 |
C. elegans; Centrosome; Microtubule; PCM; Polo-like kinase; SPD-5 |
Centrosomes are major microtubule-organizing centers composed of centrioles surrounded by an extensive proteinacious layer called the pericentriolar material (PCM). In Caenorhabditis elegans embryos, the mitotic PCM expands by Polo-like kinase 1 (PLK-1) phosphorylation-accelerated assembly of SPD-5 molecules into supramolecular scaffolds. However, how PLK-1 phosphorylation regulates SPD-5 assembly is not known. We found that a mutant version of SPD-5 that is insensitive to PLK-1 phosphorylation (SPD-54A) could localize to PCM but was unable to rescue the reduction in PCM size and density when wild-type SPD-5 levels were decreased. In vitro, purified SPD-54A self-assembled into functional supramolecular scaffolds over long time scales, suggesting that phosphorylation only controls the rate of SPD-5 scaffold assembly. Furthermore, the SPD-5 scaffold, once assembled, remained intact and supported microtubule nucleation in the absence of PLK-1 activity in vivo We conclude that PLK-1 is required for rapid assembly of the PCM scaffold but not for scaffold maintenance or function. Based on this idea, we developed a theoretical model that adequately predicted PCM growth rates in different mutant conditions in vivo We propose that PLK-1 phosphorylation-dependent conversion of SPD-5 into an assembly-competent form underlies PCM formation in vivo and that the rate of this conversion determines final PCM size and density. |
|
Arulmozhivarman G, Stöter M, Bickle M, Kräter M, Wobus M, Ehninger G, Stölzel F, Brand M, Bornhäuser M, Shayegi N
|
In Vivo Chemical Screen in Zebrafish Embryos Identifies Regulators of Hematopoiesis Using a Semiautomated Imaging Assay.
|
J Biomol Screen. 2016 Oct;21(9):956-64
|
|
Medical Biology
|

|
27112172 |
automated imaging; cmyb; hematopoietic stem cells; in vivo screen; zebrafish |
Hematopoietic stem and progenitor cells (HSPCs) generate all cell types of the blood and are crucial for homeostasis of all blood lineages in vertebrates. Hematopoietic stem cell transplantation (HSCT) is a rapidly evolving technique that offers potential cure for hematologic cancers, such as leukemia or lymphoma. HSCT may be autologous or allogenic. Successful HSCT depends critically on the abundance of engraftment-competent HSPCs, which are currently difficult to obtain in large numbers. Therefore, finding compounds that enhance either the number or the activity of HSPCs could improve prognosis for patients undergoing HSCT and is of great clinical interest. We developed a semiautomated screening method for whole zebrafish larvae using conventional liquid handling equipment and confocal microscopy. Applying this pipeline, we screened 550 compounds in triplicate for proliferation of HSPCs in vivo and identified several modulators of hematopoietic stem cell activity. One identified hit was valproic acid (VPA), which was further validated as a compound that expands and maintains the population of HSPCs isolated from human peripheral blood ex vivo. In summary, our in vivo zebrafish imaging screen identified several potential drug candidates with clinical relevance and could easily be further expanded to screen more compounds |
|
Taverna E, Mora-Bermúdez F, Strzyz PJ, Florio M, Icha J, Haffner C, Norden C, Wilsch-Bräuninger M, Huttner WB
|
Non-canonical features of the Golgi apparatus in bipolar epithelial neural stem cells.
|
ci Rep. 2016 Feb 16;6:21206
|
|
Neurobiology
|

|
26879757 |
|
Apical radial glia (aRG), the stem cells in developing neocortex, are unique bipolar epithelial cells, extending an apical process to the ventricle and a basal process to the basal lamina. Here, we report novel features of the Golgi apparatus, a central organelle for cell polarity, in mouse aRGs. The Golgi was confined to the apical process but not associated with apical centrosome(s). In contrast, in aRG-derived, delaminating basal progenitors that lose apical polarity, the Golgi became pericentrosomal. The aRG Golgi underwent evolutionarily conserved, accordion-like compression and extension concomitant with cell cycle-dependent nuclear migration. Importantly, in line with endoplasmic reticulum but not Golgi being present in the aRG basal process, its plasma membrane contained glycans lacking Golgi processing, consistent with direct ER-to-cell surface membrane traffic. Our study reveals hitherto unknown complexity of neural stem cell polarity, differential Golgi contribution to their specific architecture, and fundamental Golgi re-organization upon cell fate change. |
|
Florio M, Namba T, Pääbo S, Hiller M, Huttner WB
|
A single splice site mutation in human-specific ARHGAP11B causes basal progenitor amplification.
|
Sci Adv. 2016 Dec 7;2(12):e1601941
|
|
Neurobiology
|

|
27957544 |
ARHGAP11B; RhoGAP; basal progenitors; brain size; gene duplication; human evolution; human-specific gene; neocortex; neocortical expansion; neurogenesis |
The gene ARHGAP11B promotes basal progenitor amplification and is implicated in neocortex expansion. It arose on the human evolutionary lineage by partial duplication of ARHGAP11A, which encodes a Rho guanosine triphosphatase-activating protein (RhoGAP). However, a lack of 55 nucleotides in ARHGAP11B mRNA leads to loss of RhoGAP activity by GAP domain truncation and addition of a human-specific carboxy-terminal amino acid sequence. We show that these 55 nucleotides are deleted by mRNA splicing due to a single C?G substitution that creates a novel splice donor site. We reconstructed an ancestral ARHGAP11B complementary DNA without this substitution. Ancestral ARHGAP11B exhibits RhoGAP activity but has no ability to increase basal progenitors during neocortex development. Hence, a single nucleotide substitution underlies the specific properties of ARHGAP11B that likely contributed to the evolutionary expansion of the human neocortex |
|
Visco I, Hoege C, Hyman AA, Schwille P
|
In vitro Reconstitution of a Membrane Switch Mechanism for the Polarity Protein LGL.
|
J Mol Biol. 2016 Dec 4;428(24 Pt A):4828-4842
|
|
Cell Biology
|

|
27720986 |
C. elegans; cell polarity; giant unilamellar vesicles; lethal giant larvae (LGL); synthetic biology |
Cell polarity arises from a combination of interactions between biological molecules, such as activation, inhibition, and positive or negative feedback between specific polarity units. Activation and inhibition often take place in the form of a membrane binding switch. Lethal giant larvae (LGL), a conserved regulator of cell polarity in animals, was suggested to function as such a switch. LGL localizes to both the cytoplasm and, asymmetrically, the membrane. However, the spatial regulation mechanism of LGL membrane localization has remained unclear. For systematic elucidation, we set out to reconstitute a minimal polarity unit using a model membrane, Caenorhabditis elegans LGL (LGL-1), and atypical protein kinase C (aPKC) supposed to activate the membrane switch. We identified a membrane binding sequence (MBS) in LGL-1 by a screen in vivo, reconstituted LGL-1 membrane binding in vitro, and successfully implemented the membrane switch by aPKC phosphorylation activity, detaching LGL from membranes. Upon membrane binding, LGL-1 MBS folds into an alpha-helix in which three regions can be identified: a positively charged patch, a switch area containing the three aPKC phosphorylation sites, and a hydrophobic area probably buried in the membrane. Phosphorylation by aPKC dramatically reduces the binding affinity of the LGL-1 MBS to negatively charged model membranes, inducing its detachment. Specific residues in the MBS are critical for LGL-1 function in C. elegans. |
|
Thamm K, Graupner S, Werner C, Huttner WB, Corbeil D
|
Monoclonal Antibodies 13A4 and AC133 Do Not Recognize the Canine Ortholog of Mouse and Human Stem Cell Antigen Prominin-1 (CD133).
|
PLoS One. 2016 Oct 4;11(10):e0164079
|
|
Medical Biology
|

|
27701459 |
|
The pentaspan membrane glycoprotein prominin-1 (CD133) is widely used in medicine as a cell surface marker of stem and cancer stem cells. It has opened new avenues in stem cell-based regenerative therapy and oncology. This molecule is largely used with human samples or the mouse model, and consequently most biological tools including antibodies are directed against human and murine prominin-1. Although the general structure of prominin-1 including its membrane topology is conserved throughout the animal kingdom, its primary sequence is poorly conserved. Thus, it is unclear if anti-human and -mouse prominin-1 antibodies cross-react with their orthologs in other species, especially dog. Answering this issue is imperative in light of the growing number of studies using canine prominin-1 as an antigenic marker. Here, we address this issue by cloning the canine prominin-1 and use its overexpression as a green fluorescent protein fusion protein in Madin-Darby canine kidney cells to determine its immunoreactivity with antibodies against human or mouse prominin-1. We used immunocytochemistry, flow cytometry and immunoblotting techniques and surprisingly found no cross-species immunoreactivity. These results raise some caution in data interpretation when anti-prominin-1 antibodies are used in interspecies studies. |
|
Bhattarai P, Thomas AK, Cosacak MI, Papadimitriou C, Mashkaryan V, Froc C, Reinhardt S, Kurth T, Dahl A, Zhang Y, Kizil C
|
IL4/STAT6 Signaling Activates Neural Stem Cell Proliferation and Neurogenesis upon Amyloid-β42 Aggregation in Adult Zebrafish Brain.
|
Cell Rep. 2016 Oct 18;17(4):941-948
|
- LMF CMCB
- EMF & Histo CMCB
|
Neurobiology
|

|
27760324 |
Alzheimer’s disease; Amyloid-β42; STAT6; inflammation; interlukin-4; neural stem cell; neuro-immune crosstalk; neurodegeneration; regeneration; zebrafish |
Human brains are prone to neurodegeneration, given that endogenous neural stem/progenitor cells (NSPCs) fail to support neurogenesis. To investigate the molecular programs potentially mediating neurodegeneration-induced NSPC plasticity in regenerating organisms, we generated an Amyloid-β42 (Aβ42)-dependent neurotoxic model in adult zebrafish brain through cerebroventricular microinjection of cell-penetrating Aβ42 derivatives. Aβ42 deposits in neurons and causes phenotypes reminiscent of amyloid pathophysiology: apoptosis, microglial activation, synaptic degeneration, and learning deficits. Aβ42 also induces NSPC proliferation and enhanced neurogenesis. Interleukin-4 (IL4) is activated primarily in neurons and microglia/macrophages in response to Aβ42 and is sufficient to increase NSPC proliferation and neurogenesis via STAT6 phosphorylation through the IL4 receptor in NSPCs. Our results reveal a crosstalk between neurons and immune cells mediated by IL4/STAT6 signaling, which induces NSPC plasticity in zebrafish brains. |
|
Gröger P, Poulsen N, Klemm J, Kröger N, Schlierf M
|
Establishing super-resolution imaging for proteins in diatom biosilica
|
Sci Rep. 2016 Nov 9;6:36824
|
|
Imaging Technologies Development
|

|
27827427 |
|
The intricate, genetically controlled biosilica nano- and micropatterns produced by diatoms are a testimony for biology's ability to control mineral formation (biomineralization) at the nanoscale and regarded as paradigm for nanotechnology. Previously, several protein families involved in diatom biosilica formation have been identified, and many of them remain tightly associated with the final biosilica structure. Determining the locations of biosilica-associated proteins with high precision is, therefore expected to provide clues to their roles in biosilica morphogenesis. To achieve this, we introduce here single-molecule localization microscopy to diatoms based on photo-activated light microscopy (PALM) to overcome the diffraction limit. We identified six photo-convertible fluorescent proteins (FPs) that can be utilized for PALM in the cytoplasm of model diatom Thalassiosira pseudonana. However, only three FPs were also functional when embedded in diatom biosilica. These were employed for PALM-based localization of the diatom biosilica-associated protein Silaffin-3 (tpSil3) with a mean precision of 25 nm. This allowed for the identification of distinct accumulation areas of Sil3 in the biosilica, which cannot be resolved by confocal fluorescence microscopy. The enhanced microscopy technique introduced here for diatoms will aid in elucidating the molecular mechanism of silica biomineralization as well as other aspects of diatom cell biology. |
|
Niehage C, Karbanová J, Steenblock C, Corbeil D, Hoflack B
|
Cell Surface Proteome of Dental Pulp Stem Cells Identified by Label-Free Mass Spectrometry.
|
PLoS One. 2016 Aug 4;11(8):e0159824
|
|
Cell Biology
|

|
27490675 |
|
Multipotent mesenchymal stromal cells (MSCs) are promising tools for regenerative medicine. They can be isolated from different sources based on their plastic-adherence property. The identification of reliable cell surface markers thus becomes the Holy Grail for their prospective isolation. Here, we determine the cell surface proteomes of human dental pulp-derived MSCs isolated from single donors after culture expansion in low (2%) or high (10%) serum-containing media. Cell surface proteins were tagged on intact cells using cell impermeable, cleavable sulfo-NHS-SS-biotin, which allows their enrichment by streptavidin pull-down. For the proteomic analyses, we first compared label-free methods to analyze cell surface proteomes i.e. composition, enrichment and proteomic differences, and we developed a new mathematical model to determine cell surface protein enrichment using a combinatorial gene ontology query. Using this workflow, we identified 101 cluster of differentiation (CD) markers and 286 non-CD cell surface proteins. Based on this proteome profiling, we identified 14 cell surface proteins, which varied consistently in abundance when cells were cultured under low or high serum conditions. Collectively, our analytical methods provide a basis for identifying the cell surface proteome of dental pulp stem cells isolated from single donors and its evolution during culture or differentiation. Our data provide a comprehensive cell surface proteome for the precise identification of dental pulp-derived MSC populations and their isolation for potential therapeutic intervention. |
|
Reichert D, Scheinpflug J, Karbanová J, Freund D, Bornhäuser M, Corbeil D
|
Tunneling nanotubes mediate the transfer of stem cell marker CD133 between hematopoietic progenitor cells.
|
Exp Hematol. 2016 Nov;44(11):1092-1112.e2
|
- LMF CMCB
- EMF & Histo CMCB
|
Cell Biology
|

|
27473566 |
|
Deciphering all mechanisms of intercellular communication used by hematopoietic progenitors is important, not only for basic stem cell research, but also in view of their therapeutic relevance. Here, we investigated whether these cells can produce the thin F-actin-based plasma membrane protrusions referred to as tunneling nanotubes (TNTs), which are known to bridge cells over long distances without contact with the substratum and transfer cargo molecules along them in various biological processes. We found that human primary CD34+ hematopoietic progenitors and leukemic KG1a cells develop such structures upon culture on primary mesenchymal stromal cells or specific extracellular-matrix-based substrata. Time-lapse video microscopy revealed that cell dislodgement is the primary mechanism responsible for TNT biogenesis. Surprisingly, we found that, among various cluster of differentiation (CD) markers, only the stem cell antigen CD133 is transferred between cells. It is selectively and directionally transported along the surface of TNTs in small clusters, such as cytoplasmic phospho-myosin light chain 2, suggesting that the latter actin motor protein might be implicated in this process. Our data provide new insights into the biology of hematopoietic progenitors that can contribute to our understanding of all facets of intercellular communication in the bone marrow microenvironment under healthy or cancerous conditions. |
|
Taubenberger AV, Bray LJ, Haller B, Shaposhnykov A, Binner M, Freudenberg U, Guck J, Werner C
|
3D extracellular matrix interactions modulate tumour cell growth, invasion and angiogenesis in engineered tumour microenvironments.
|
Acta Biomater. 2016 May;36:73-85
|
- LMF CMCB
- EMF & Histo CMCB
|
Cell Biology
|

|
26971667 |
3D model; Angiogenesis; Extracellular matrix; Integrin; Tumour microenvironment |
Interactions between tumour cells and extracellular matrix proteins of the tumour microenvironment play crucial roles in cancer progression. So far, however, there are only a few experimental platforms available that allow us to study these interactions systematically in a mechanically defined three-dimensional (3D) context. Here, we have studied the effect of integrin binding motifs found within common extracellular matrix (ECM) proteins on 3D breast (MCF-7) and prostate (PC-3, LNCaP) cancer cell cultures, and co-cultures with endothelial and mesenchymal stromal cells. For this purpose, matrix metalloproteinase-degradable biohybrid poly(ethylene) glycol-heparin hydrogels were decorated with the peptide motifs RGD, GFOGER (collagen I), or IKVAV (laminin-111). Over 14 days, cancer spheroids of 100-200 um formed. While the morphology of poorly invasive MCF-7 and LNCaP cells was not modulated by any of the peptide motifs, the aggressive PC-3 cells exhibited an invasive morphology when cultured in hydrogels comprising IKVAV and GFOGER motifs compared to RGD motifs or nonfunctionalised controls. PC-3 (but not MCF-7 and LNCaP) cell growth and endothelial cell infiltration were also significantly enhanced in IKVAV and GFOGER presenting gels. Taken together, we have established a 3D culture model that allows for dissecting the effect of biochemical cues on processes relevant to early cancer progression. These findings provide a basis for more mechanistic studies that may further advance our understanding of how ECM modulates cancer cell invasion and how to ultimately interfere with this process.
STATEMENT OF SIGNIFICANCE:
Threedimensional in vitro cancer models have generated great interest over the past decade. However, most models are not suitable to systematically study the effects of environmental cues on cancer development and progression. To overcome this limitation, we have developed an innovative hydrogel platform to study the interactions between breast and prostate cancer cells and extracellular matrix ligands relevant to the tumour microenvironment. Our results show that hydrogels with laminin- and collagen-derived adhesive peptides induce a malignant phenotype in a cell-line specific manner. Thus, we have identified a method to control the incorporation of biochemical cues within a three dimensional culture model and anticipate that it will help us in better understanding the effects of the tumour microenvironment on cancer progression. |
|
Schürmann M, Scholze J, Müller P, Guck J, Chan CJ
|
Cell nuclei have lower refractive index and mass density than cytoplasm.
|
J Biophotonics. 2016 Oct;9(10):1068-1076
|
|
Biophysics
|

|
27010098 |
digital holographic microscopy; mass density; nucleus; quantitative phase imaging; refractive index |
Common perception regards the nucleus as a densely packed object with higher refractive index (RI) and mass density than the surrounding cytoplasm. Here, the volume of isolated nuclei is systematically varied by electrostatic and osmotic conditions as well as drug treatments that modify chromatin conformation. The refractive index and dry mass of isolated nuclei is derived from quantitative phase measurements using digital holographic microscopy (DHM). Surprisingly, the cell nucleus is found to have a lower RI and mass density than the cytoplasm in four different cell lines and throughout the cell cycle. This result has important implications for conceptualizing light tissue interactions as well as biological processes in cells. |
|
Sztacho M, Segeletz S, Sanchez-Fernandez MA, Czupalla C, Niehage C, Hoflack B
|
BAR Proteins PSTPIP1/2 Regulate Podosome Dynamics and the Resorption Activity of Osteoclasts.
|
PLoS One. 2016 Oct 19;11(10):e0164829
|
|
Cell Biology
|

|
27760174 |
|
Bone resorption in vertebrates relies on the ability of osteoclasts to assemble F-actin-rich podosomes that condense into podosomal belts, forming sealing zones. Sealing zones segregate bone-facing ruffled membranes from other membrane domains, and disassemble when osteoclasts migrate to new areas. How podosome/sealing zone dynamics is regulated remains unknown. We illustrate the essential role of the membrane scaffolding F-BAR-Proline-Serine-Threonine Phosphatase Interacting Proteins (PSTPIP) 1 and 2 in this process. Whereas PSTPIP2 regulates podosome assembly, PSTPIP1 regulates their disassembly. PSTPIP1 recruits, through its F-BAR domain, the protein tyrosine phosphatase non-receptor type 6 (PTPN6) that de-phosphophorylates the phosphatidylinositol 5-phosphatases SHIP1/2 bound to the SH3 domain of PSTPIP1. Depletion of any component of this complex prevents sealing zone disassembly and increases osteoclast activity. Thus, our results illustrate the importance of BAR domain proteins in podosome structure and dynamics, and identify a new PSTPIP1/PTPN6/SHIP1/2-dependent negative feedback mechanism that counterbalances Src and PI(3,4,5)P3 signalling to control osteoclast cell polarity and activity during bone resorption |
|
Papanikos F, Daniel K, Goercharn-Ramlal A, Fei JF, Kurth T, Wojtasz L, Dereli I, Fu J, Penninger J, Habermann B, Surani A, Stewart AF, Toth A
|
The enigmatic meiotic dense body and its newly discovered component, SCML1, are dispensable for fertility and gametogenesis in mice.
|
Chromosoma. 2017 Jun;126(3):399-415
|
|
Cell Biology
|

|
27165042 |
Dense body; Meiosis; Polycomb; Transposon; piRNA |
Meiosis is a critical phase in the life cycle of sexually reproducing organisms. Chromosome numbers are halved during meiosis, which requires meiosis-specific modification of chromosome behaviour. Furthermore, suppression of transposons is particularly important during meiosis to allow the transmission of undamaged genomic information between generations. Correspondingly, specialized genome defence mechanisms and nuclear structures characterize the germ line during meiosis. Survival of mammalian spermatocytes requires that the sex chromosomes form a distinct silenced chromatin domain, called the sex body. An enigmatic spherical DNA-negative structure, called the meiotic dense body, forms in association with the sex body. The dense body contains small non-coding RNAs including microRNAs and PIWI-associated RNAs. These observations gave rise to speculations that the dense body may be involved in sex body formation and or small non-coding RNA functions, e.g. the silencing of transposons. Nevertheless, the function of the dense body has remained mysterious because no protein essential for dense body formation has been reported yet. We discovered that the polycomb-related sex comb on midleg-like 1 (SCML1) is a meiosis-specific protein and is an essential component of the meiotic dense body. Despite abolished dense body formation, Scml1-deficient mice are fertile and proficient in sex body formation, transposon silencing and in timely progression through meiosis and gametogenesis. Thus, we conclude that dense body formation is not an essential component of the gametogenetic program in the mammalian germ line. |
|
Aurich F, Dahmann C
|
A Mutation in fat2 Uncouples Tissue Elongation from Global Tissue Rotation.
|
Cell Rep. 2016 Mar 22;14(11):2503-10
|
|
Developmental Biology
|

|
26972006 |
|
Global tissue rotation was proposed as a morphogenetic mechanism controlling tissue elongation. In Drosophila ovaries, global tissue rotation of egg chambers coincides with egg chamber elongation. Egg chamber rotation was put forward to result in circumferential alignment of extracellular fibers. These fibers serve as molecular corsets to restrain growth of egg chambers perpendicular to the anteroposterior axis, thereby leading to the preferential egg chamber elongation along this axis. The atypical cadherin Fat2 is required for egg chamber elongation, rotation, and the circumferential alignment of extracellular fibers. Here, we have generated a truncated form of Fat2 that lacks the entire intracellular region. fat2 mutant egg chambers expressing this truncated protein fail to rotate yet display normal extracellular fiber alignment and properly elongate. Our data suggest that global tissue rotation, even though coinciding with tissue elongation, is not a necessary prerequisite for elongation. |
|
Michel M, Aliee M, Rudolf K, Bialas L, Jülicher F, Dahmann C
|
The Selector Gene apterous and Notch Are Required to Locally Increase Mechanical Cell Bond Tension at the Drosophila Dorsoventral Compartment Boundary.
|
PLoS One. 2016 Aug 23;11(8):e0161668
|
|
Developmental Biology
|

|
27552097 |
|
The separation of cells with distinct fates and functions is important for tissue and organ formation during animal development. Regions of different fates within tissues are often separated from another along straight boundaries. These compartment boundaries play a crucial role in tissue patterning and growth by stably positioning organizers. In Drosophila, the wing imaginal disc is subdivided into a dorsal and a ventral compartment. Cells of the dorsal, but not ventral, compartment express the selector gene apterous. Apterous expression sets in motion a gene regulatory cascade that leads to the activation of Notch signaling in a few cell rows on either side of the dorsoventral compartment boundary. Both Notch and apterous mutant clones disturb the separation of dorsal and ventral cells. Maintenance of the straight shape of the dorsoventral boundary involves a local increase in mechanical tension at cell bonds along the boundary. The mechanisms by which cell bond tension is locally increased however remain unknown. Here we use a combination of laser ablation of cell bonds, quantitative image analysis, and genetic mutants to show that Notch and Apterous are required to increase cell bond tension along the dorsoventral compartment boundary. Moreover, clonal expression of the Apterous target gene capricious results in cell separation and increased cell bond tension at the clone borders. Finally, using a vertex model to simulate tissue growth, we find that an increase in cell bond tension at the borders of cell clones, but not throughout the cell clone, can lead to cell separation. We conclude that Apterous and Notch maintain the characteristic straight shape of the dorsoventral compartment boundary by locally increasing cell bond tension. |
|
Toutouna L, Nikolakopoulou P, Poser SW, Masjkur J, Arps-Forker C, Troullinaki M, Grossklaus S, Bosak V, Friedrich U, Ziemssen T, Bornstein SR, Chavakis T, Androutsellis-Theotokis A
|
Hes3 expression in the adult mouse brain is regulated during demyelination and remyelination.
|
Brain Res. 2016 Jul 1;1642:124-130
|
|
Neurobiology
|

|
27018293 |
Brain; Hes3; Myelin; Oligodendrocyte precursor; Regeneration |
Hes3 is a component of the STAT3-Ser/Hes3 Signaling Axis controlling the growth and survival of neural stem cells and other plastic cells. Pharmacological activation of this pathway promotes neuronal rescue and behavioral recovery in models of ischemic stroke and Parkinson's disease. Here we provide initial observations implicating Hes3 in the cuprizone model of demyelination and remyelination. We focus on the subpial motor cortex of mice because we detected high Hes3 expression. This area is of interest as it is impacted both in human demyelinating diseases and in the cuprizone model. We report that Hes3 expression is reduced at peak demyelination and is partially restored within 1 week after cuprizone withdrawal. This raises the possibility of Hes3 involvement in demyelination/remyelination that may warrant additional research. Supporting a possible role of Hes3 in the maintenance of oligodendrocyte markers, a Hes3 null mouse strain shows lower levels of myelin basic protein in undamaged adult mice, compared to wild-type controls. We also present a novel method for culturing the established oligodendrocyte progenitor cell line oli-neu in a manner that maintains Hes3 expression as well as its self-renewal and differentiation potential, offering an experimental tool to study Hes3. Based upon this approach, we identify a Janus kinase inhibitor and dbcAMP as powerful inducers of Hes3 gene expression. We provide a new biomarker and cell culture method that may be of interest in demyelination/remyelination research. |
|
Stein R, Kapplusch F, Heymann MC, Russ S, Staroske W, Hedrich CM, Rösen-Wolff A, Hofmann SR
|
Enzymatically Inactive Procaspase 1 stabilizes the ASC Pyroptosome and Supports Pyroptosome Spreading during Cell Division.
|
J Biol Chem. 2016 Aug 26;291(35):18419-29
|
|
Medical Biology
|

|
27402835 |
ASC; IL-1; IL-1beta; NLRP3; apoptosis-associated speck-like protein containing a CARD; caspase 1 (CASP1); imaging; inflammasome; interleukin 1-converting enzyme; pyroptosome |
Caspase-1 is a key player during the initiation of pro-inflammatory innate immune responses, activating pro-IL-1beta in so-called inflammasomes. A subset of patients with recurrent febrile episodes and systemic inflammation of unknown origin harbor mutations in CASP1 encoding caspase-1. CASP1 variants result in reduced enzymatic activity of caspase-1 and impaired IL-1beta secretion. The apparent paradox of reduced IL-1? secretion but systemic inflammation led to the hypothesis that CASP1 mutations may result in variable protein interaction clusters, thus activating alternative signaling pathways. To test this hypothesis, we established and characterized an in vitro system of transduced immortalized murine macrophages expressing either WT or enzymatically inactive (p.C284A) procaspase-1 fusion reporter proteins. Macrophages with variant p.C284A caspase-1 did not secrete IL-1beta and exhibited reduced inflammatory cell death, referred to as pyroptosis. Caspase-1 and apoptosis-associated speck-like protein containing a CARD (ASC) formed cytosolic macromolecular complexes (so-called pyroptosomes) that were significantly increased in number and size in cells carrying the p.C284A caspase-1 variant compared with WT caspase-1. Furthermore, enzymatically inactive caspase-1 interacted with ASC longer and with increased intensity compared with WT caspase-1. Applying live cell imaging, we documented for the first time that pyroptosomes containing enzymatically inactive variant p.C284A caspase-1 spread during cell division. In conclusion, variant p.C284A caspase-1 stabilizes pyroptosome formation, potentially enhancing inflammation by two IL-1beta-independent mechanisms: pyroptosomes convey an enhanced inflammatory stimulus through the recruitment of additional proteins (such as RIP2, receptor interacting protein kinase 2), which is further amplified through pyroptosome and cell division. |
|
Wolf C, Rapp A, Berndt N, Staroske W, Schuster M, Dobrick-Mattheuer M, Kretschmer S, König N, Kurth T, Wieczorek D, Kast K, Cardoso MC, Günther C, Lee-Kirsch MA
|
RPA and Rad51 constitute a cell intrinsic mechanism to protect the cytosol from self DNA.
|
Nat Commun. 2016 May 27;7:11752
|
- LMF CMCB
- EMF & Histo CMCB
- LMF & EMF CFCI
|
Medical Biology
|

|
27230542 |
|
Immune recognition of cytosolic DNA represents a central antiviral defence mechanism. Within the host, short single-stranded DNA (ssDNA) continuously arises during the repair of DNA damage induced by endogenous and environmental genotoxic stress. Here we show that short ssDNA traverses the nuclear membrane, but is drawn into the nucleus by binding to the DNA replication and repair factors RPA and Rad51. Knockdown of RPA and Rad51 enhances cytosolic leakage of ssDNA resulting in cGAS-dependent type I IFN activation. Mutations in the exonuclease TREX1 cause type I IFN-dependent autoinflammation and autoimmunity. We demonstrate that TREX1 is anchored within the outer nuclear membrane to ensure immediate degradation of ssDNA leaking into the cytosol. In TREX1-deficient fibroblasts, accumulating ssDNA causes exhaustion of RPA and Rad51 resulting in replication stress and activation of p53 and type I IFN. Thus, the ssDNA-binding capacity of RPA and Rad51 constitutes a cell intrinsic mechanism to protect the cytosol from self DNA. |
|
Walker TL, Overall RW, Vogler S, Sykes AM, Ruhwald S, Lasse D, Ichwan M, Fabel K, Kempermann G
|
Lysophosphatidic Acid Receptor Is a Functional Marker of Adult Hippocampal Precursor Cells.
|
Stem Cell Reports. 2016 Apr 12;6(4):552-565
|
|
Neurobiology
|

|
27050949 |
|
Here, we show that the lysophosphatidic acid receptor 1 (LPA1) is expressed by a defined population of type 1 stem cells and type 2a precursor cells in the adult mouse dentate gyrus. LPA1, in contrast to Nestin, also marks the quiescent stem cell population. Combining LPA1-GFP with EGFR and prominin-1 expression, we have enabled the prospective separation of both proliferative and non-proliferative precursor cell populations. Transcriptional profiling of the isolated proliferative precursor cells suggested immune mechanisms and cytokine signaling as molecular regulators of adult hippocampal precursor cell proliferation. In addition to LPA1 being a marker of this important stem cell population, we also show that the corresponding ligand LPA is directly involved in the regulation of adult hippocampal precursor cell proliferation and neurogenesis, an effect that can be attributed to LPA signaling via the AKT and MAPK pathways. |
|
Wagenführ L, Meyer AK, Marrone L, Storch A
|
Oxygen Tension Within the Neurogenic Niche Regulates Dopaminergic Neurogenesis in the Developing Midbrain.
|
Stem Cells Dev. 2016 Feb 1;25(3):227-38
|
|
Neurobiology
|

|
26577812 |
|
Oxygen tension is an important factor controlling stem cell proliferation and maintenance in various stem cell populations with a particular relevance in midbrain dopaminergic progenitors. Further studies have shown that the oxygen-dependent transcription factor hypoxia-inducible factor 1alpha (HIF-1alpha) is involved in these processes. However, all available studies on oxygen effects in dopaminergic neuroprogenitors were performed in vitro and thus it remains unclear whether tissue oxygen tension in the embryonic midbrain is also relevant for the regulation of dopaminergic neurogenesis in vivo. We thus dissect here the effects of oxygen tension in combination with HIF-1alpha conditional knockout on dopaminergic neurogenesis by using a novel experimental design allowing for the control of oxygen tension within the microenvironment of the neurogenic niche of the murine fetal midbrain in vivo. The microenvironment of the midbrain dopaminergic neurogenic niche was detected as hypoxic with oxygen tensions below 1.1%. Maternal oxygen treatment of 10%, 21%, and 75% atmospheric oxygen tension for 48 h translates into robust changes in fetal midbrain oxygenation. Fetal midbrain hypoxia hampered the generation of dopaminergic neurons and is accompanied with restricted fetal midbrain development. In contrast, induced hyperoxia stimulated proliferation and differentiation of dopaminergic progenitors during early and late embryogenesis. Oxygen effects were not directly mediated through HIF-1alpha signaling. These data--in agreement with in vitro data-indicate that oxygen is a crucial regulator of developmental dopaminergic neurogenesis. Our study provides the initial framework for future studies on molecular mechanisms mediating oxygen regulation of dopaminergic neurogenesis within the fetal midbrain as its natural environment. |
|
Schütz K, Despang F, Lode A, Gelinsky M
|
Cell-laden biphasic scaffolds with anisotropic structure for the regeneration of osteochondral tissue.
|
J Tissue Eng Regen Med. 2016 May;10(5):404-17
|
|
Medical Biology
|
|
24644134 |
alginate; biomimetic; biphasic scaffold; cell embedding; mesenchymal stem cells; osteochondral |
Sufficient treatment of chondral and osteochondral defects to restore function of the respective tissue remains challenging in regenerative medicine. Biphasic scaffolds that mimic properties of bone and cartilage are appropriate to regenerate both tissues at the same time. The present study describes the development of biphasic, but monolithic scaffolds based on alginate, which are suitable for embedding of living cells in the chondral part. Scaffolds are fabricated under sterile and cell-compatible conditions according to the principle of diffusion-controlled, directed ionotropic gelation, which leads to the formation of channel-like, parallel aligned pores, running through the whole length of the biphasic constructs. The synthesis process leads to an anisotropic structure, as it is found in many natural tissues. The two different layers of the scaffolds are characterized by different microstructure and mechanical properties which provide a suitable environment for cells to form the respective tissue. Human chondrocytes and human mesenchymal stem cells were embedded within the chondral layer of the biphasic scaffolds during hydrogel formation and their chondrogenic (re)differentiation was successfully induced. Whereas viability of non-induced human mesenchymal stem cells decreased during culture, cell viability of human chondrocytes and chondrogenically induced human mesenchymal stem cells remained high within the scaffolds over the whole culture period of 3 weeks, demonstrating successful fabrication of cell-laden centimetre-scaled constructs for potential application in regenerative treatment of osteochondral defects. |
|
Fabig G, Müller-Reichert T, Paliulis LV
|
Back to the roots: segregation of univalent sex chromosomes in meiosis.
|
Chromosoma. 2016 Jun;125(2):277-86.
|
|
Cell Biology
|

|
26511278 |
C. elegans; Chromosome segregation; Male meiosis; Nematodes; Sex chromosomes; Univalent chromosomes |
In males of many taxa, univalent sex chromosomes normally segregate during the first meiotic division, and analysis of sex chromosome segregation was foundational for the chromosome theory of inheritance. Correct segregation of single or multiple univalent sex chromosomes occurs in a cellular environment where every other chromosome is a bivalent that is being partitioned into homologous chromosomes at anaphase I. The mechanics of univalent chromosome segregation vary among animal taxa. In some, univalents establish syntelic attachment of sister kinetochores to the spindle. In others, amphitelic attachment is established. Here, we review how this problem of segregation of unpaired chromosomes is solved in different animal systems. In addition, we give a short outlook of how mechanistic insights into this process could be gained by explicitly studying model organisms, such as Caenorhabditis elegans. |
|
Kourtzelis I1, Kotlabova K, Lim JH, Mitroulis I, Ferreira A, Chen LS, Gercken B, Steffen A, Kemter E, Klotzsche-von Ameln A, Waskow C, Hosur K, Chatzigeorgiou A, Ludwig B, Wolf E, Hajishengallis G, Chavakis T.
|
Developmental endothelial locus-1 modulates platelet-monocyte interactions and instant blood-mediated inflammatory reaction in islet transplantation.
|
Thromb Haemost. 2016 Apr;115(4):781-8.
|
|
Medical Biology
|

|
26676803 |
Developmental endothelial locus 1 (Del-1); GPIb; Instant blood-mediated inflammatory reaction (IBMIR); Mac-1 integrin; coagulation; islet transplantation; platelet-monocyte aggregates |
Platelet-monocyte interactions are strongly implicated in thrombo-inflammatory injury by actively contributing to intravascular inflammation, leukocyte recruitment to inflamed sites, and the amplification of the procoagulant response. Instant blood-mediated inflammatory reaction (IBMIR) represents thrombo-inflammatory injury elicited upon pancreatic islet transplantation (islet-Tx), thereby dramatically affecting transplant survival and function. Developmental endothelial locus-1 (Del-1) is a functionally versatile endothelial cell-derived homeostatic factor with anti-inflammatory properties, but its potential role in IBMIR has not been previously addressed. Here, we establish Del-1 as a novel inhibitor of IBMIR using a whole blood-islet model and a syngeneic murine transplantation model. Indeed, Del-1 pre-treatment of blood before addition of islets diminished coagulation activation and islet damage as assessed by C-peptide release. Consistently, intraportal islet-Tx in transgenic mice with endothelial cell-specific overexpression of Del-1 resulted in a marked decrease of monocytes and platelet-monocyte aggregates in the transplanted tissues, relative to those in wild-type recipients. Mechanistically, Del-1 decreased platelet-monocyte aggregate formation, by specifically blocking the interaction between monocyte Mac-1-integrin and platelet GPIb. Our findings reveal a hitherto unknown role of Del-1 in the regulation of platelet-monocyte interplay and the subsequent heterotypic aggregate formation in the context of IBMIR. Therefore, Del-1 may represent a novel approach to prevent or mitigate the adverse reactions mediated through thrombo-inflammatory pathways in islet-Tx and perhaps other inflammatory disorders involving platelet-leukocyte aggregate formation. |
|
Lode A, Meyer M, Brüggemeier S, Paul B, Baltzer H, Schröpfer M, Winkelmann C, Sonntag F, Gelinsky M
|
Additive manufacturing of collagen scaffolds by three-dimensional plotting of highly viscous dispersions.
|
Biofabrication. 2016 Feb 27;8(1):015015
|
|
Medical Biology
|

|
26924825 |
|
Additive manufacturing (AM) allows the free form fabrication of three-dimensional (3D) structures with distinct external geometry, fitting into a patient-specific defect, and defined internal pore architecture. However, fabrication of predesigned collagen scaffolds using AM-based technologies is challenging due to the low viscosity of collagen solutions, gels or dispersions commonly used for scaffold preparation. In the present study, we have developed a straightforward method which is based on 3D plotting of a highly viscous, high density collagen dispersion. The swollen state of the collagen fibrils at pH 4 enabled the homogenous extrusion of the material, the deposition of uniform strands and finally the construction of 3D scaffolds. Stabilization of the plotted structures was achieved by freeze-drying and chemical crosslinking with the carbodiimide EDC. The scaffolds exhibited high shape and dimensional fidelity and a hierarchical porosity consisting of macropores generated by strand deposition as well as an interconnected microporosity within the strands as result of the freeze-drying process. Cultivation of human mesenchymal stromal cells on the scaffolds, with and without adipogenic or osteogenic stimulation, revealed their cytocompatibility and potential applicability for adipose and bone tissue engineering. |
|
Peitzsch C, Cojoc M, Hein L, Kurth I, Mäbert K, Trautmann F, Klink B, Schröck E, Wirth MP, Krause M, Stakhovsky EA, Telegeev GD, Novotny V, Toma M, Muders M, Baretton GB, Frame FM, Maitland NJ, Baumann M, Dubrovska A
|
An Epigenetic Reprogramming Strategy to Resensitize Radioresistant Prostate Cancer Cells.
|
Cancer Res. 2016 May 1;76(9):2637-51
|
|
Medical Biology
|

|
26984757 |
|
Radiotherapy is a mainstay of curative prostate cancer treatment, but risks of recurrence after treatment remain significant in locally advanced disease. Given that tumor relapse can be attributed to a population of cancer stem cells (CSC) that survives radiotherapy, analysis of this cell population might illuminate tactics to personalize treatment. However, this direction remains challenging given the plastic nature of prostate cancers following treatment. We show here that irradiating prostate cancer cells stimulates a durable upregulation of stem cell markers that epigenetically reprogram these cells. In both tumorigenic and radioresistant cell populations, a phenotypic switch occurred during a course of radiotherapy that was associated with stable genetic and epigenetic changes. Specifically, we found that irradiation triggered histone H3 methylation at the promoter of the CSC marker aldehyde dehydrogenase 1A1 (ALDH1A1), stimulating its gene transcription. Inhibiting this methylation event triggered apoptosis, promoted radiosensitization, and hindered tumorigenicity of radioresistant prostate cancer cells. Overall, our results suggest that epigenetic therapies may restore the cytotoxic effects of irradiation in radioresistant CSC populations |
|
Fanourgakis G, Lesche M, Akpinar M, Dahl A, Jessberger R
|
Chromatoid Body Protein TDRD6 Supports Long 3' UTR Triggered Nonsense Mediated mRNA Decay.
|
PLoS Genet. 2016 May 5;12(5):e1005857
|
|
Cell Biology
|

|
27149095 |
|
Chromatoid bodies (CBs) are spermiogenesis-specific organelles of largely unknown function. CBs harbor various RNA species, RNA-associated proteins and proteins of the tudor domain family like TDRD6, which is required for a proper CB architecture. Proteome analysis of purified CBs revealed components of the nonsense-mediated mRNA decay (NMD) machinery including UPF1. TDRD6 is essential for UPF1 localization to CBs, for UPF1-UPF2 and UPF1-MVH interactions. Upon removal of TDRD6, the association of several mRNAs with UPF1 and UPF2 is disturbed, and the long 3' UTR-stimulated but not the downstream exon-exon junction triggered pathway of NMD is impaired. Reduced association of the long 3' UTR mRNAs with UPF1 and UPF2 correlates with increased stability and enhanced translational activity. Thus, we identified TDRD6 within CBs as required for mRNA degradation, specifically the extended 3' UTR-triggered NMD pathway, and provide evidence for the requirement of NMD in spermiogenesis. This function depends on TDRD6-promoted assembly of mRNA and decay enzymes in CBs. |
|
Klein K, Werner K, Teske C, Schenk M, Giese T, Weitz J, Welsch T
|
Role of TFEB-driven autophagy regulation in pancreatic cancer treatment.
|
Int J Oncol. 2016 Jul;49(1):164-72.
|
|
Medical Biology
|

|
27175909 |
|
Autophagy pathways promote the growth of pancreatic ductal adenocarcinoma (PDAC), but the critical role is yet to be determined. Transcription factor EB (TFEB) centrally controls lysosomal and autophagy biogenesis. This study aimed to explore the role of TFEB for autophagy regulation in PDAC. We found that TFEB expression was significantly elevated in human PDAC samples (n=45), and localized to the cytoplasm and nucleus in 11 of 15 cases. In primary PDAC cell lines, TFEB nuclear expression was evident even under basal conditions, and further nuclear enrichment was achieved by starvation. Transient RNA interference reduced TFEB expression to 11-23%, but starvation-induced accumulation of the lipidated, autophagosome-associated LC3-II and the autophago-to-lysosome route was maintained after TFEB silencing. Likewise, gemcitabine treatment of the cancer cells augmented apoptosis and LC3-II as an indicator of autophagy, regardless of the TFEB expression levels. Moreover, the interplay of oncogenic KRAS with TFEB and autophagy was investigated. KRAS silencing caused PDAC cell apoptosis and a reciprocal increase in TFEB expression. This inverse correlation could be confirmed in published data sets of genetically engineered mouse models and human PDAC samples using the the Pubmed GEO and BioPortal databases, and was independent of KRAS mutation status. In conclusion, the central autophagy regulator TFEB is expressed and active in PDAC, but autophagy is sustained after TFEB knockdown, suggesting alternative bypass signaling. TFEB is dispensable for gemcitabine-induced cell death, but inversely correlated with KRAS expression. |
|
Wiedemuth R, Klink B, Fujiwara M, Schröck E, Tatsuka M, Schackert G, Temme A
|
Janus face-like effects of Aurora B inhibition: antitumoral mode of action versus induction of aneuploid progeny.
|
Carcinogenesis. 2016 Oct;37(10):993-1003
|
|
Medical Biology
|

|
27515963 |
|
The mitotic Aurora B kinase is overexpressed in tumors and various inhibitors for Aurora B are currently under clinical assessments. However, when considering Aurora B kinase inhibitors as anticancer drugs, their mode of action and the role of p53 status as a possible predictive factor for response still needs to be investigated. In this study, we analyzed the effects of selective Aurora B inhibition using AZD1152-HQPA/Barasertib (AZD1152) on HCT116 cells, U87-MG, corresponding isogenic p53-deficient cells and a primary glioblastoma cell line. AZD1152 treatment caused polyploidy and non-apoptotic cell death in all cell lines irrespective of p53 status and was accompanied by poly-merotelic kinetochore-microtubule attachments and DNA damage. In p53 wild-type cells a DNA damage response induced an inefficient pseudo-G1 cell cycle arrest, which was not able to halt ongoing endoreplication of cells. Of note, release of tumor cells from AZD1152 resulted in recovery of aneuploid progenies bearing numerical and structural chromosomal aberrations. Yet, AZD1152 treatment enhanced death receptor TRAIL-R2 levels in all tumor cell lines investigated. A concomitant increase of the activating natural killer (NK) cell ligand MIC A/B in p53-deficient cells and an induction of FAS/CD95 in cells containing p53 rendered AZD1152-treated cells more susceptible for NK-cell-mediated lysis. Our study mechanistically explains a p53-independent mode of action of a chemical Aurora B inhibitor and suggests a potential triggering of antitumoral immune responses, following polyploidization of tumor cells, which might constrain recovery of aneuploid tumor cells. |
|
Gossla E, Tonndorf R, Bernhardt A, Kirsten M, Hund RD, Aibibu D, Cherif C, Gelinsky M
|
Electrostatic flocking of chitosan fibres leads to highly porous, elastic and fully biodegradable anisotropic scaffolds.
|
Acta Biomater. 2016 Oct 15;44:267-76
|
|
Medical Biology
|

|
27544815 |
Biodegradable scaffold; Chitosan; Chitosan fibre; Flock technology; Tissue engineering |
Electrostatic flocking - a common textile technology which has been applied in industry for decades - is based on the deposition of short polymer fibres in a parallel aligned fashion on flat or curved substrates, covered with a layer of a suitable adhesive. Due to their highly anisotropic properties the resulting velvet-like structures can be utilised as scaffolds for tissue engineering applications in which the space between the fibres can be defined as pores. In the present study we have developed a fully resorbable compression elastic flock scaffold from a single material system based on chitosan. The fibres and the resulting scaffolds were analysed concerning their structural and mechanical properties and the biocompatibility was tested in vitro. The tensile strength and Young's modulus of the chitosan fibres were analysed as a function of the applied sterilisation technique (ethanol, supercritical carbon dioxide, gamma-irradiation and autoclaving). All sterilisation methods decreased the Young's modulus (from 14GPa to 6-12GPa). The tensile strength was decreased after all treatments - except after the autoclaving of chitosan fibres submerged in water. Compressive strength of the highly porous flock scaffolds was 18±6kPa with a elastic modulus in the range of 50-100kPa. The flocked scaffolds did not show any cytotoxic effect during indirect or direct culture of human mesenchymal stem cells or the sarcoma osteogenic cell line Saos-2. Furthermore cell adhesion and proliferation of both cell types could be observed. This is the first demonstration of a fully biodegradable scaffold manufactured by electrostatic flocking.
STATEMENT OF SIGNIFICANCE:
Most tissues possess anisotropic fibrous structures. In contrast, most of the commonly used scaffolds have an isotropic morphology. By utilising the textile technology of electrostatic flocking, highly porous and clearly anisotropic scaffolds can be manufactured. Flocking leads to parallel aligned short fibres, glued on the surface of a substrate. Such structures are characterised by a high and adjustable porosity, accompanied by distinct stiffness in fibre direction. The present article describes for the first time a fully biodegradable flock scaffold, solely made of chitosan. Utilisation of only one material for manufacturing of flock substrate, adhesive and fibres allow a uniform degradation of the whole construct. Such a new type of scaffold can be of great interest for a variety of biomedical applications. |
|
Zurnic I, Hütter S, Rzeha U, Stanke N, Reh J, Müllers E, Hamann MV, Kern T, Gerresheim GK, Lindel F, Serrao E, Lesbats P, Engelman AN, Cherepanov P, Lindemann D
|
Interactions of Prototype Foamy Virus Capsids with Host Cell Polo-Like Kinases Are Important for Efficient Viral DNA Integration.
|
PLoS Pathog. 2016 Aug 31;12(8):e1005860
|
|
Cell Biology
|

|
27579920 |
|
Unlike for other retroviruses, only a few host cell factors that aid the replication of foamy viruses (FVs) via interaction with viral structural components are known. Using a yeast-two-hybrid (Y2H) screen with prototype FV (PFV) Gag protein as bait we identified human polo-like kinase 2 (hPLK2), a member of cell cycle regulatory kinases, as a new interactor of PFV capsids. Further Y2H studies confirmed interaction of PFV Gag with several PLKs of both human and rat origin. A consensus Ser-Thr/Ser-Pro (S-T/S-P) motif in Gag, which is conserved among primate FVs and phosphorylated in PFV virions, was essential for recognition by PLKs. In the case of rat PLK2, functional kinase and polo-box domains were required for interaction with PFV Gag. Fluorescently-tagged PFV Gag, through its chromatin tethering function, selectively relocalized ectopically expressed eGFP-tagged PLK proteins to mitotic chromosomes in a Gag STP motif-dependent manner, confirming a specific and dominant nature of the Gag-PLK interaction in mammalian cells. The functional relevance of the Gag-PLK interaction was examined in the context of replication-competent FVs and single-round PFV vectors. Although STP motif mutated viruses displayed wild type (wt) particle release, RNA packaging and intra-particle reverse transcription, their replication capacity was decreased 3-fold in single-cycle infections, and up to 20-fold in spreading infections over an extended time period. Strikingly similar defects were observed when cells infected with single-round wt Gag PFV vectors were treated with a pan PLK inhibitor. Analysis of entry kinetics of the mutant viruses indicated a post-fusion defect resulting in delayed and reduced integration, which was accompanied with an enhanced preference to integrate into heterochromatin. We conclude that interaction between PFV Gag and cellular PLK proteins is important for early replication steps of PFV within host cells. |
|
Rahmig S, Kronstein-Wiedemann R, Fohgrub J, Kronstein N, Nevmerzhitskaya A, Bornhäuser M, Gassmann M, Platz A, Ordemann R, Tonn T, Waskow C
|
Improved Human Erythropoiesis and Platelet Formation in Humanized NSGW41 Mice.
|
Stem Cell Reports. 2016 Oct 11;7(4):591-601
|
|
Medical Biology
|

|
27618723 |
|
Human erythro-megakaryopoiesis does not occur in humanized mouse models, preventing the in vivo analysis of human hematopoietic stem cell (HSC) differentiation into these lineages in a surrogate host. Here we show that stably engrafted KIT-deficient NOD/SCID Il2rg-/-KitW41/W41 (NSGW41) mice support much improved human erythropoiesis and platelet formation compared with irradiated NSG recipients. Considerable numbers of human erythroblasts and mature thrombocytes are present in the bone marrow and blood, respectively. Morphology, composition, and enucleation capacity of de novo generated human erythroblasts in NSGW41 mice are comparable with those in human bone marrow. Overexpression of human erythropoietin showed no further improvement in human erythrocyte output, but depletion of macrophages led to the appearance of human erythrocytes in the blood. Human erythropoiesis up to normoblasts and platelet formation is fully supported in NSGW41 mice, allowing the analysis of human HSC differentiation into these lineages, the exploration of certain pathophysiologies, and the evaluation of gene therapeutic approaches. |
|
Mziaut H, Mulligan B, Hoboth P, Otto O, Ivanova A, Herbig M, Schumann D, Hildebrandt T, Dehghany J, Sönmez A, Münster C, Meyer-Hermann M, Guck J, Kalaidzidis Y, Solimena M
|
The F-actin modifier villin regulates insulin granule dynamics and exocytosis downstream of islet cell autoantigen 512.
|
Mol Metab. 2016 Jun 10;5(8):656-68
|
|
Medical Biology
|

|
27656403 |
F-actin Granules Ica512 Insulin Secretion Villin |
OBJECTIVE:
Insulin release from pancreatic islet beta cells should be tightly controlled to avoid hypoglycemia and insulin resistance. The cortical actin cytoskeleton is a gate for regulated exocytosis of insulin secretory granules (SGs) by restricting their mobility and access to the plasma membrane. Prior studies suggest that SGs interact with F-actin through their transmembrane cargo islet cell autoantigen 512 (Ica512) (also known as islet antigen 2/Ptprn). Here we investigated how Ica512 modulates SG trafficking and exocytosis.
METHODS:
Transcriptomic changes in Ica512 (-/-) mouse islets were analyzed. Imaging as well as biophysical and biochemical methods were used to validate if and how the Ica512-regulated gene villin modulates insulin secretion in mouse islets and insulinoma cells.
RESULTS:
The F-actin modifier villin was consistently downregulated in Ica512 (-/-) mouse islets and in Ica512-depleted insulinoma cells. Villin was enriched at the cell cortex of ? cells and dispersed villin (-/-) islet cells were less round and less deformable. Basal mobility of SGs in villin-depleted cells was enhanced. Moreover, in cells depleted either of villin or Ica512 F-actin cages restraining cortical SGs were enlarged, basal secretion was increased while glucose-stimulated insulin release was blunted. The latter changes were reverted by overexpressing villin in Ica512-depleted cells, but not vice versa.
CONCLUSION:
Our findings show that villin controls the size of the F-actin cages restricting SGs and, thus, regulates their dynamics and availability for exocytosis. Evidence that villin acts downstream of Ica512 also indicates that SGs directly influence the remodeling properties of the cortical actin cytoskeleton for tight control of insulin secretion. |
|
Kurlishchuk Y, Vynnytska-Myronovska B, Grosse-Gehling P, Bobak Y, Manig F, Chen O, Merker SR, Henle T, Löck S, Stange DE, Stasyk O, Kunz-Schughart LA
|
Co-application of canavanine and irradiation uncouples anticancer potential of arginine deprivation from citrulline availability.
|
Oncotarget. 2016 Nov 8;7(45):73292-73308
|
|
Medical Biology
|

|
27689335 |
ASS1 expression; CRC spheroids; arginine deprivation; colorectal cancer (CRC); normal colon organoids |
The moderate anticancer effect of arginine deprivation in clinical trials has been linked to an induced argininosuccinate synthetase (ASS1) expression in initially ASS1-negative tumors, and ASS1-positive cancers are anticipated as non-responders. Our previous studies indicated that arginine deprivation and low doses of the natural arginine analog canavanine can enhance radioresponse. However, the efficacy of the proposed combination in the presence of extracellular citrulline, the substrate for arginine synthesis by ASS1, remains to be elucidated, in particular for malignant cells with positive and/or inducible ASS1 as in colorectal cancer (CRC). Here, the physiological citrulline concentration of 0.05 mM was insufficient to overcome cell cycle arrest and radiosensitization triggered by arginine deficiency. Hyperphysiological citrulline (0.4 mM) did not entirely compensate for the absence of arginine and significantly decelerated cell cycling. Similar levels of canavanine-induced apoptosis were detected in the absence of arginine regardless of citrulline supplementation both in 2-D and advanced 3-D assays, while normal colon epithelial cells in organoid/colonosphere culture were unaffected. Notably, canavanine tremendously enhanced radiosensitivity of arginine-starved 3-D CRC spheroids even in the presence of hyperphysiological citrulline. We conclude that the novel combinatorial targeting strategy of metabolic-chemo-radiotherapy has great potential for the treatment of malignancies with inducible ASS1 expression. |
|
Akkineni AR1, Ahlfeld T, Lode A, Gelinsky M
|
A versatile method for combining different biopolymers in a core/shell fashion by 3D plotting to achieve mechanically robust constructs.
|
Biofabrication. 2016 Oct 7;8(4):045001.
|
|
Medical Biology
|

|
27716641 |
|
Three-dimensional extrusion of two different biomaterials in a core/shell (c/s) fashion has gained much interest in the last couple of years as it allows for fabricating constructs with novel and interesting properties. We now demonstrate that combining high concentrated (16.7 wt%) alginate hydrogels as shell material with low concentrated, soft biopolymer hydrogels as core leads to mechanically stable and robust 3D scaffolds. Alginate, chitosan, gellan gum, gelatin and collagen hydrogels were utilized successfully as core materials-hydrogels which are too soft for 3D plotting of open-porous structures without an additional mechanical support. The respective c/s scaffolds were characterized concerning their morphology, mechanical properties and swelling behavior. It could be shown that core as well as shell part can be loaded with growth factors and that the release depends on core composition and shell thickness. Neither the plotting process nor the crosslinking with 1M CaCl2 denatured the proteins. When core and shell were loaded with different growth factors (VEGF and BMP-2, respectively) a dual release was achieved. Finally, live human endothelial cells were integrated in the core material, demonstrating that this new strategy can be used for bioprinting purposes as well. |
|
Vogel S, Arnoldini S, Möller S, Schnabelrauch M, Hempel U
|
Sulfated hyaluronan alters fibronectin matrix assembly and promotes osteogenic differentiation of human bone marrow stromal cells.
|
Sci Rep. 2016 Nov 3;6:36418
|
|
Cell Biology
|

|
27808176 |
|
Extracellular matrix (ECM) composition and structural integrity is one of many factors that influence cellular differentiation. Fibronectin (FN) which is in many tissues the most abundant ECM protein forms a unique fibrillary network. FN homes several binding sites for sulfated glycosaminoglycans (sGAG), such as heparin (Hep), which was previously shown to influence FN conformation and protein binding. Synthetically sulfated hyaluronan derivatives (sHA) can serve as model molecules with a well characterized sulfation pattern to study sGAG-FN interaction. Here is shown that the low-sulfated sHA (sHA1) interacts with FN and influences fibril assembly. The interaction of FN fibrils with sHA1 and Hep, but not with non-sulfated HA was visualized by immunofluorescent co-staining. FRET analysis of FN confirmed the presence of more extended fibrils in human bone marrow stromal cells (hBMSC)-derived ECM in response to sHA1 and Hep. Although both sHA1 and Hep affected FN conformation, exclusively sHA1 increased FN protein level and led to thinner fibrils. Further, only sHA1 had a pro-osteogenic effect and enhanced the activity of tissue non-specific alkaline phosphatase. We hypothesize that the sHA1-triggered change in FN assembly influences the entire ECM network and could be the underlying mechanism for the pro-osteogenic effect of sHA1 on hBMSC. |
|
Roscher A, Hasegawa T, Dohnke S, Ocaña-Morgner C, Amizuka N, Jessberger R, Garbe AI
|
The F-actin modulator SWAP-70 controls podosome patterning in osteoclasts.
|
Bone Rep. 2016 Jul 19;5:214-221
|
|
Medical Biology
|

|
28580389 |
Actin cytoskeleton; Membrane binding; PIP3; Podosome pattering; Swap-70; V-ATPase |
Osteoclasts are bone resorbing cells acting as key mediators of bone disorders. Upon adhesion to bone, osteoclasts polarize and reorganize their cytoskeleton to generate a ring-like F-actin-rich structure, the sealing zone, wherein the osteoclast's resorptive organelle, the ruffled border, is formed. The dynamic self-organization of actin-rich adhesive structures, the podosomes, from clusters to belts is crucial for osteoclast-mediated bone degradation. Mice lacking the protein SWAP-70 display an osteopetrotic phenotype due to defective bone resorption caused by impaired actin ring formation in Swap-70-/- osteoclasts. To further elucidate the mechanisms underlying this defect, we investigated the specific function of SWAP-70 in the organization and dynamics of podosomes. These detailed studies show that the transition from podosome clusters to rings is impaired in Swap-70-/- osteoclasts. Live cell imaging of dynamic F-actin turnover and SWAP-70 localization during podosome patterning indicate that SWAP-70 is dispensable for cluster formation but plays a key role in F-actin ring generation. Our data provide insights in the role of SWAP-70's F-actin binding domain and pleckstrin homology (PH) domain in the proper localization of SWAP-70 and formation of a peripheral podosome belt, respectively. Ex vivo bone analyses revealed that SWAP-70-deficient osteoclasts exhibit defective ruffled border formation and V-ATPase expression. Our findings suggest an important role of membrane binding of SWAP-70 for the regulation of actin dynamics, which is essential for podosome patterning, and thus for the resorptive activity of osteoclasts. |
|
Mestres I, Chuang JZ, Calegari F, Conde C, Sung CH
|
SARA regulates neuronal migration during neocortical development through L1 trafficking.
|
Development. 2016 Sep 1;143(17):3143-53.
|
|
Neurobiology
|
|
27471254 |
Adhesion; Cortical neuron migration; Endosomal trafficking; L1CAM; SARA; Zfyve9 |
Emerging evidence suggests that endocytic trafficking of adhesion proteins plays a crucial role in neuronal migration during neocortical development. However, molecular insights into these processes remain elusive. Here, we study the early endosomal protein Smad anchor for receptor activation (SARA) in the developing mouse brain. SARA is enriched at the apical endfeet of radial glia of the neocortex. Although SARA knockdown did not lead to detectable neurogenic phenotypes, SARA-suppressed neurons exhibited impaired orientation and migration across the intermediate zone. Mechanistically, we show that SARA knockdown neurons exhibit increased surface expression of the L1 cell adhesion molecule. Neurons ectopically expressing L1 phenocopy the migration and orientation defects caused by SARA knockdown and display increased contact with neighboring neurites. L1 knockdown effectively rescues SARA suppression-induced phenotypes. SARA knockdown neurons eventually overcome their migration defect and enter later into the cortical plate. Nevertheless, these neurons localize at more superficial cortical layers than their control counterparts. These results suggest that SARA regulates the orientation, multipolar-to-bipolar transition and the positioning of cortical neurons via modulating surface L1 expression. |
|
Ferrando-May E, Hartmann H, Reymann J, Ansari N, Utz N, Fried HU, Kukat C, Peychl J, Liebig C, Terjung S, Laketa V, Sporbert A, Weidtkamp-Peters S, Schauss A, Zuschratter W, Avilov S; German BioImaging network
|
Advanced light microscopy core facilities: Balancing service, science and career.
|
Microsc Res Tech. 2016 Jun;79(6):463-79
|
|
Imaging Technologies Development
|
|
27040755 |
core facility administration; instrument performance tests; microscopy room requirements; user and staff training; user/staff/instrument ratio |
Core Facilities (CF) for advanced light microscopy (ALM) have become indispensable support units for research in the life sciences. Their organizational structure and technical characteristics are quite diverse, although the tasks they pursue and the services they offer are similar. Therefore, throughout Europe, scientists from ALM-CFs are forming networks to promote interactions and discuss best practice models. Here, we present recommendations for ALM-CF operations elaborated by the workgroups of the German network of ALM-CFs, German Bio-Imaging (GerBI). We address technical aspects of CF planning and instrument maintainance, give advice on the organization and management of an ALM-CF, propose a scheme for the training of CF users, and provide an overview of current resources for image processing and analysis. Further, we elaborate on the new challenges and opportunities for professional development and careers created by CFs. While some information specifically refers to the German academic system, most of the content of this article is of general interest for CFs in the life sciences. |
|
Weber M, Scherf N, Meyer AM, Panáková D, Kohl P, Huisken J
|
Cell-accurate optical mapping across the entire developing heart.
|
Elife. 2017 Dec 29;6. pii: e28307
|
|
Imaging Technologies Development
|

|
29286002 |
Cardiac conduction; Cardiology; Light sheet microscopy; Optical mapping; Organogenesis; biophysics; developmental biology; image analysis; stem cells; structural biology; zebrafish |
Organogenesis depends on orchestrated interactions between individual cells and morphogenetically relevant cues at the tissue level. This is true for the heart, whose function critically relies on well-ordered communication between neighboring cells, which is established and fine-tuned during embryonic development. For an integrated understanding of the development of structure and function, we need to move from isolated snap-shot observations of either microscopic or macroscopic parameters to simultaneous and, ideally continuous, cell-to-organ scale imaging. We introduce cell-accurate three-dimensional Ca2+-mapping of all cells in the entire electro-mechanically uncoupled heart during the looping stage of live embryonic zebrafish, using high-speed light sheet microscopy and tailored image processing and analysis. We show how myocardial region-specific heterogeneity in cell function emerges during early development and how structural patterning goes hand-in-hand with functional maturation of the entire heart. Our method opens the way to systematic, scale-bridging, in vivo studies of vertebrate organogenesis by cell-accurate structure-function mapping across entire organs. |
|
Solimena M, Schulte AM, Marselli L, Ehehalt F, Richter D, Kleeberg M, Mziaut H, Knoch KP, Parnis J, Bugliani M, Siddiq A, Jörns A, Burdet F, Liechti R, Suleiman M, Margerie D, Syed F, Distler M, Grützmann R, Petretto E, Moreno-Moral A, Wegbrod C, Sönmez A, Pfriem K, Friedrich A, Meinel J, Wollheim CB, Baretton GB, Scharfmann R, Nogoceke E, Bonifacio E, Sturm D, Meyer-Puttlitz B, Boggi U, Saeger HD, Filipponi F, Lesche M, Meda P, Dahl A, Wigger L, Xenarios I, Falchi M, Thorens B, Weitz J, Bokvist K, Lenzen S, Rutter GA, Froguel P, von Bülow M, Ibberson M, Marchetti P
|
Systems biology of the IMIDIA biobank from organ donors and pancreatectomised patients defines a novel transcriptomic signature of islets from individuals with type 2 diabetes.
|
Diabetologia. 2017 Nov 28
|
|
Medical Biology
|

|
29185012 |
Beta cell; Biobank; Diabetes; Gene expression; Insulin secretion; Islet; Laser capture microdissection; Organ donor; Pancreatectomy; Systems biology |
AIMS/HYPOTHESIS:
Pancreatic islet beta cell failure causes type 2 diabetes in humans. To identify transcriptomic changes in type 2 diabetic islets, the Innovative Medicines Initiative for Diabetes: Improving beta-cell function and identification of diagnostic biomarkers for treatment monitoring in Diabetes (IMIDIA) consortium ( www.imidia.org ) established a comprehensive, unique multicentre biobank of human islets and pancreas tissues from organ donors and metabolically phenotyped pancreatectomised patients (PPP).
METHODS:
Affymetrix microarrays were used to assess the islet transcriptome of islets isolated either by enzymatic digestion from 103 organ donors (OD), including 84 non-diabetic and 19 type 2 diabetic individuals, or by laser capture microdissection (LCM) from surgical specimens of 103 PPP, including 32 non-diabetic, 36 with type 2 diabetes, 15 with impaired glucose tolerance (IGT) and 20 with recent-onset diabetes (<1 year), conceivably secondary to the pancreatic disorder leading to surgery (type 3c diabetes). Bioinformatics tools were used to (1) compare the islet transcriptome of type 2 diabetic vs non-diabetic OD and PPP as well as vs IGT and type 3c diabetes within the PPP group; and (2) identify transcription factors driving gene co-expression modules correlated with insulin secretion ex vivo and glucose tolerance in vivo. Selected genes of interest were validated for their expression and function in beta cells.
RESULTS:
Comparative transcriptomic analysis identified 19 genes differentially expressed (false discovery rate ≤0.05, fold change ≥1.5) in type 2 diabetic vs non-diabetic islets from OD and PPP. Nine out of these 19 dysregulated genes were not previously reported to be dysregulated in type 2 diabetic islets. Signature genes included TMEM37, which inhibited Ca2+-influx and insulin secretion in beta cells, and ARG2 and PPP1R1A, which promoted insulin secretion. Systems biology approaches identified HNF1A, PDX1 and REST as drivers of gene co-expression modules correlated with impaired insulin secretion or glucose tolerance, and 14 out of 19 differentially expressed type 2 diabetic islet signature genes were enriched in these modules. None of these signature genes was significantly dysregulated in islets of PPP with impaired glucose tolerance or type 3c diabetes.
CONCLUSIONS/INTERPRETATION:
These studies enabled the stringent definition of a novel transcriptomic signature of type 2 diabetic islets, regardless of islet source and isolation procedure. Lack of this signature in islets from PPP with IGT or type 3c diabetes indicates differences possibly due to peculiarities of these hyperglycaemic conditions and/or a role for duration and severity of hyperglycaemia. Alternatively, these transcriptomic changes capture, but may not precede, beta cell failure. |
|
Shevchenko A, Yang Y, Knaust A, Verbavatz JM, Mai H, Wang B, Wang C, Shevchenko A
|
Open sesame: Identification of sesame oil and oil soot ink in organic deposits of Tang Dynasty lamps from Astana necropolis in China.
|
PLoS One. 2017 Feb 24;12(2):e0158636
|
|
|

|
28234998 |
|
Lamp illuminants evidence the exploitation of natural resources, animal and plant domestication, commerce, religious practices and nutrition of ancient populations. However, the physicochemical analysis of their major constituent-burned, degraded and aged mixture of triacylglycerols is imprecise and may lead to ambiguous interpretations. We applied proteomics to analyze fuel deposits from eight lamps dated by 6th to 8th centuries AD that were excavated at the Astana necropolis (Xinjiang, China) and determined their origin by identifying organism-specific proteins. Proteomics evidence corroborated and detailed the assignments of source organism relying upon comparative profiling of intact triacylglycerols by shotgun lipidomics. We found that ruminant (mostly, sheep) fat, cattle ghee and sesame oil were common combustibles in Astana and concluded that sesame as an oilseed appeared in China under Tang Dynasty concomitantly with the expansion of Buddhism. |
|
Chakraborty D, Paszkowski-Rogacz M, Berger N, Ding L, Mircetic J, Fu J, Iesmantavicius V, Choudhary C, Anastassiadis K, Stewart AF, Buchholz F
|
lncRNA Panct1 Maintains Mouse Embryonic Stem Cell Identity by Regulating TOBF1 Recruitment to Oct-Sox Sequences in Early G1.
|
Cell Rep. 2017 Dec 12;21(11):3012-3021
|
|
Cell Biology
|

|
29241531 |
Panct1; TOBF1; cell cycle; lncRNAs; pluripotency |
Long noncoding RNAs (lncRNAs) have been implicated in diverse biological processes, including embryonic stem cell (ESC) maintenance. However, their functional mechanisms remain largely undefined. Here, we show that the lncRNA Panct1 regulates the transient recruitment of a putative X-chromosome-encoded protein A830080D01Rik, hereafter referred to as transient octamer binding factor 1 (TOBF1), to genomic sites resembling the canonical Oct-Sox motif. TOBF1 physically interacts with Panct1 and exhibits a cell-cycle-specific punctate localization in ESCs. At the chromatin level, this correlates with its recruitment to promoters of pluripotency genes. Strikingly, mutating an octamer-like motif in Panct1 RNA abrogates the strength of TOBF1 localization and recruitment to its targets. Taken together, our data reveal a tightly controlled spatial and temporal pattern of lncRNA-mediated gene regulation in a cell-cycle-dependent manner and suggest that lncRNAs might function as barcodes for identifying genomic addresses for maintaining cellular states. |
|
Zuber R, Norum M, Wang Y, Oehl K, Gehring N, Accardi D, Bartozsewski S, Berger J, Flötenmeyer M, Moussian B
|
The ABC transporter Snu and the extracellular protein Snsl cooperate in the formation of the lipid-based inward and outward barrier in the skin of Drosophila.
|
Eur J Cell Biol. 2017 Dec 27. pii: S0171-9335(17)30185-1
|
|
Cell Biology
|

|
29306642 |
|
Lipids in extracellular matrices (ECM) contribute to barrier function and stability of epithelial tissues such as the pulmonary alveoli and the skin. In insects, skin waterproofness depends on the outermost layer of the extracellular cuticle termed envelope that contains cuticulin, an unidentified water-repellent complex molecule composed of proteins, lipids and catecholamines. Based on live-imaging analyses of fruit fly larvae, we find that initially envelope units are assembled within putative vesicles harbouring the ABC transporter Snu and the extracellular protein Snsl. In a second step, the content of these vesicles is distributed to cuticular lipid-transporting nanotubes named pore canals and to the cuticle surface in dependence of Snu function. Consistently, the surface of snu and snsl mutant larvae is depleted from lipids and cuticulin. By consequence, these animals suffer uncontrolled water loss and penetration of xenobiotics. Our data allude to a two-step model of envelope i.e. barrier formation. The proposed mechanism in principle parallels the events occurring during differentiation of the lipid-based ECM by keratinocytes in the vertebrate skin suggesting establishment of analogous mechanisms of skin barrier formation in vertebrates and invertebrates. |
|
Patel A, Malinovska L, Saha S, Wang J, Alberti S, Krishnan Y, Hyman AA
|
ATP as a biological hydrotrope.
|
Science. 2017 May 19;356(6339):753-756
|
|
Cell Biology
|

|
28522535 |
|
Hydrotropes are small molecules that solubilize hydrophobic molecules in aqueous solutions. Typically, hydrotropes are amphiphilic molecules and differ from classical surfactants in that they have low cooperativity of aggregation and work at molar concentrations. Here, we show that adenosine triphosphate (ATP) has properties of a biological hydrotrope. It can both prevent the formation of and dissolve previously formed protein aggregates. This chemical property is manifested at physiological concentrations between 5 and 10 millimolar. Therefore, in addition to being an energy source for biological reactions, for which micromolar concentrations are sufficient, we propose that millimolar concentrations of ATP may act to keep proteins soluble. This may in part explain why ATP is maintained in such high concentrations in cells. |
|
Mateju D, Franzmann TM, Patel A, Kopach A, Boczek EE, Maharana S, Lee HO, Carra S, Hyman AA, Alberti S
|
An aberrant phase transition of stress granules triggered by misfolded protein and prevented by chaperone function.
|
EMBO J. 2017 Jun 14;36(12):1669-1687
|
|
Cell Biology
|

|
28377462 |
SOD1; protein aggregation; protein misfolding; proteostasis; stress granules |
Stress granules (SG) are membrane-less compartments involved in regulating mRNAs during stress. Aberrant forms of SGs have been implicated in age-related diseases, such as amyotrophic lateral sclerosis (ALS), but the molecular events triggering their formation are still unknown. Here, we find that misfolded proteins, such as ALS-linked variants of SOD1, specifically accumulate and aggregate within SGs in human cells. This decreases the dynamics of SGs, changes SG composition, and triggers an aberrant liquid-to-solid transition of in vitro reconstituted compartments. We show that chaperone recruitment prevents the formation of aberrant SGs and promotes SG disassembly when the stress subsides. Moreover, we identify a backup system for SG clearance, which involves transport of aberrant SGs to the aggresome and their degradation by autophagy. Thus, cells employ a system of SG quality control to prevent accumulation of misfolded proteins and maintain the dynamic state of SGs, which may have relevance for ALS and related diseases. |
|
Morelli FF, Verbeek DS, Bertacchini J, Vinet J, Mediani L, Marmiroli S, Cenacchi G, Nasi M, De Biasi S, Brunsting JF, Lammerding J, Pegoraro E, Angelini C, Tupler R, Alberti S, Carra S
|
Aberrant Compartment Formation by HSPB2 Mislocalizes Lamin A and Compromises Nuclear Integrity and Function.
|
Cell Rep. 2017 Aug 29;20(9):2100-2115
|
|
Cell Biology
|

|
28854361 |
congenital myopathy; lamin-A/C; nucleus; phase transition; small HSPs |
Small heat shock proteins (HSPBs) contain intrinsically disordered regions (IDRs), but the functions of these IDRs are still unknown. Here, we report that, in mammalian cells, HSPB2 phase separates to form nuclear compartments with liquid-like properties. We show that phase separation requires the disordered C-terminal domain of HSPB2. We further demonstrate that, in differentiating myoblasts, nuclear HSPB2 compartments sequester lamin A. Increasing the nuclear concentration of HSPB2 causes the formation of aberrant nuclear compartments that mislocalize lamin A and chromatin, with detrimental consequences for nuclear function and integrity. Importantly, phase separation of HSPB2 is regulated by HSPB3, but this ability is lost in two identified HSPB3 mutants that are associated with myopathy. Our results suggest that HSPB2 phase separation is involved in reorganizing the nucleoplasm during myoblast differentiation. Furthermore, these findings support the idea that aberrant HSPB2 phase separation, due to HSPB3 loss-of-function mutations, contributes to myopathy. |
|
Hernández-Vega A, Braun M, Scharrel L, Jahnel M, Wegmann S, Hyman BT, Alberti S, Diez S, Hyman AA
|
Local Nucleation of Microtubule Bundles through Tubulin Concentration into a Condensed Tau Phase.
|
Cell Rep. 2017 Sep 5;20(10):2304-2312
|
|
Cell Biology
|

|
28877466 |
cytoskeleton; drops; intrinsically disordered proteins; liquid-like; microtubule bundles; multivalency; nucleation; phase separation; tau; tubulin |
Non-centrosomal microtubule bundles play important roles in cellular organization and function. Although many diverse proteins are known that can bundle microtubules, biochemical mechanisms by which cells could locally control the nucleation and formation of microtubule bundles are understudied. Here, we demonstrate that the concentration of tubulin into a condensed, liquid-like compartment composed of the unstructured neuronal protein tau is sufficient to nucleate microtubule bundles. We show that, under conditions of macro-molecular crowding, tau forms liquid-like drops. Tubulin partitions into these drops, efficiently increasing tubulin concentration and driving the nucleation of microtubules. These growing microtubules form bundles, which deform the drops while remaining enclosed by diffusible tau molecules exhibiting a liquid-like behavior. Our data suggest that condensed compartments of microtubule bundling proteins could promote the local formation of microtubule bundles in neurons by acting as non-centrosomal microtubule nucleation centers and that liquid-like tau encapsulation could provide both stability and plasticity to long axonal microtubule bundles. |
|
Redemann S, Baumgart J, Lindow N, Shelley M, Nazockdast E, Kratz A, Prohaska S, Brugués J, Fürthauer S, Müller-Reichert T
|
C. elegans chromosomes connect to centrosomes by anchoring into the spindle network.
|
Nat Commun. 2017 May 11;8:15288
|
|
Cell Biology
|
|
28492281 |
|
The mitotic spindle ensures the faithful segregation of chromosomes. Here we combine the first large-scale serial electron tomography of whole mitotic spindles in early C. elegans embryos with live-cell imaging to reconstruct all microtubules in 3D and identify their plus- and minus-ends. We classify them as kinetochore (KMTs), spindle (SMTs) or astral microtubules (AMTs) according to their positions, and quantify distinct properties of each class. While our light microscopy and mutant studies show that microtubules are nucleated from the centrosomes, we find only a few KMTs directly connected to the centrosomes. Indeed, by quantitatively analysing several models of microtubule growth, we conclude that minus-ends of KMTs have selectively detached and depolymerized from the centrosome. In toto, our results show that the connection between centrosomes and chromosomes is mediated by an anchoring into the entire spindle network and that any direct connections through KMTs are few and likely very transient. |
|
Dye NA, Popović M, Spannl S, Etournay R, Kainmüller D, Ghosh S, Myers EW, Jülicher F, Eaton S
|
Cell dynamics underlying oriented growth of the Drosophila wing imaginal disc.
|
Development. 2017 Dec 1;144(23):4406-4421
|
|
Developmental Biology
|

|
29038308 |
Culture; Ecdysone; Imaginal disc; Insulin; Proliferation |
Quantitative analysis of the dynamic cellular mechanisms shaping the Drosophila wing during its larval growth phase has been limited, impeding our ability to understand how morphogen patterns regulate tissue shape. Such analysis requires explants to be imaged under conditions that maintain both growth and patterning, as well as methods to quantify how much cellular behaviors change tissue shape. Here, we demonstrate a key requirement for the steroid hormone 20-hydroxyecdysone (20E) in the maintenance of numerous patterning systems in vivo and in explant culture. We find that low concentrations of 20E support prolonged proliferation in explanted wing discs in the absence of insulin, incidentally providing novel insight into the hormonal regulation of imaginal growth. We use 20E-containing media to observe growth directly and to apply recently developed methods for quantitatively decomposing tissue shape changes into cellular contributions. We discover that whereas cell divisions drive tissue expansion along one axis, their contribution to expansion along the orthogonal axis is cancelled by cell rearrangements and cell shape changes. This finding raises the possibility that anisotropic mechanical constraints contribute to growth orientation in the wing disc. |
|
Woodruff JB, Ferreira Gomes B, Widlund PO, Mahamid J, Honigmann A, Hyman AA
|
The Centrosome Is a Selective Condensate that Nucleates Microtubules by Concentrating Tubulin.
|
Cell. 2017 Jun 1;169(6):1066-1077.e10
|
|
Cell Biology
|

|
28575670 |
Centrosome; Polo Kinase; SPD-5; TPX2; XMAP215; microtubule-organizing center; pericentriolar material; phase separation; scaffold |
Centrosomes are non-membrane-bound compartments that nucleate microtubule arrays. They consist of nanometer-scale centrioles surrounded by a micron-scale, dynamic assembly of protein called the pericentriolar material (PCM). To study how PCM forms a spherical compartment that nucleates microtubules, we reconstituted PCM-dependent microtubule nucleation in vitro using recombinant C. elegans proteins. We found that macromolecular crowding drives assembly of the key PCM scaffold protein SPD-5 into spherical condensates that morphologically and dynamically resemble in vivo PCM. These SPD-5 condensates recruited the microtubule polymerase ZYG-9 (XMAP215 homolog) and the microtubule-stabilizing protein TPXL-1 (TPX2 homolog). Together, these three proteins concentrated tubulin ∼4-fold over background, which was sufficient to reconstitute nucleation of microtubule asters in vitro. Our results suggest that in vivo PCM is a selective phase that organizes microtubule arrays through localized concentration of tubulin by microtubule effector proteins. |
|
Boothe T, Hilbert L, Heide M, Berninger L, Huttner WB, Zaburdaev V, Vastenhouw NL, Myers EW, Drechsel DN, Rink JC
|
A tunable refractive index matching medium for live imaging cells, tissues and model organisms.
|
Elife. 2017 Jul 14;6. pii: e27240
|
- LMF MPI-CBG
- Screening MPI-CBG
|
Imaging Technologies Development
|

|
28708059 |
Planaria; cell biology; confocal microscopy; developmental biology; live-imaging; organoids; refractive index matching; stem cells; zebrafish |
In light microscopy, refractive index mismatches between media and sample cause spherical aberrations that often limit penetration depth and resolution. Optical clearing techniques can alleviate these mismatches, but they are so far limited to fixed samples. We present Iodixanol as a non-toxic medium supplement that allows refractive index matching in live specimens and thus substantially improves image quality in live-imaged primary cell cultures, planarians, zebrafish and human cerebral organoids. |
|
Albert M, Kalebic N, Florio M, Lakshmanaperumal N, Haffner C, Brandl H, Henry I, Huttner WB
|
Epigenome profiling and editing of neocortical progenitor cells during development.
|
EMBO J. 2017 Sep 1;36(17):2642-2658
|
|
Neurobiology
|

|
28765163 |
Cas9; epigenome; histone methylation; neocortical development; neural progenitor cell |
The generation of neocortical neurons from neural progenitor cells (NPCs) is primarily controlled by transcription factors binding to DNA in the context of chromatin. To understand the complex layer of regulation that orchestrates different NPC types from the same DNA sequence, epigenome maps with cell type resolution are required. Here, we present genomewide histone methylation maps for distinct neural cell populations in the developing mouse neocortex. Using different chromatin features, we identify potential novel regulators of cortical NPCs. Moreover, we identify extensive H3K27me3 changes between NPC subtypes coinciding with major developmental and cell biological transitions. Interestingly, we detect dynamic H3K27me3 changes on promoters of several crucial transcription factors, including the basal progenitor regulator Eomes We use catalytically inactive Cas9 fused with the histone methyltransferase Ezh2 to edit H3K27me3 at the Eomes locus in vivo, which results in reduced Tbr2 expression and lower basal progenitor abundance, underscoring the relevance of dynamic H3K27me3 changes during neocortex development. Taken together, we provide a rich resource of neocortical histone methylation data and outline an approach to investigate its contribution to the regulation of selected genes during neocortical development. |
|
Spannl S, Kumichel A, Hebbar S, Kapp K, Gonzalez-Gaitan M, Winkler S, Blawid R, Jessberger G, Knust E
|
The Crumbs_C isoform of Drosophila shows tissue- and stage-specific expression and prevents light-dependent retinal degeneration.
|
Biol Open. 2017 Feb 15;6(2):165-175
|
|
Cell Biology
|

|
28202468 |
Alternative splicing; EGF-like repeat; Epithelial polarity; Mutually exclusive exon |
Drosophila Crumbs (Crb) is a key regulator of epithelial polarity and fulfils a plethora of other functions, such as growth regulation, morphogenesis of photoreceptor cells and prevention of retinal degeneration. This raises the question how a single gene regulates such diverse functions, which in mammals are controlled by three different paralogs. Here, we show that in Drosophila different Crb protein isoforms are differentially expressed as a result of alternative splicing. All isoforms are transmembrane proteins that differ by just one EGF-like repeat in their extracellular portion. Unlike Crb_A, which is expressed in most embryonic epithelia from early stages onward, Crb_C is expressed later and only in a subset of embryonic epithelia. Flies specifically lacking Crb_C are homozygous viable and fertile. Strikingly, these flies undergo light-dependent photoreceptor degeneration despite the fact that the other isoforms are expressed and properly localised at the stalk membrane. This allele now provides an ideal possibility to further unravel the molecular mechanisms by which Drosophila crb protects photoreceptor cells from the detrimental consequences of light-induced cell stress. |
|
Sidhaye J, Norden C
|
Concerted action of neuroepithelial basal shrinkage and active epithelial migration ensures efficient optic cup morphogenesis.
|
Elife. 2017 Apr 4;6. pii: e22689
|
|
Cell Biology
|

|
28372636 |
cell biology; collective cell migration; developmental biology; epithelial invagination; epithelial morphogenesis; retinal neuroepithelium; stem cells; zebrafish |
Organ formation is a multi-scale event that involves changes at the intracellular, cellular and tissue level. Organogenesis often starts with the formation of characteristically shaped organ precursors. However, the cellular mechanisms driving organ precursor formation are often not clear. Here, using zebrafish, we investigate the epithelial rearrangements responsible for the development of the hemispherical retinal neuroepithelium (RNE), a part of the optic cup. We show that in addition to basal shrinkage of RNE cells, active migration of connected epithelial cells into the RNE is a crucial player in its formation. This cellular movement is driven by progressive cell-matrix contacts and actively translocates prospective RNE cells to their correct location before they adopt neuroepithelial fate. Failure of this migration during neuroepithelium formation leads to ectopic determination of RNE cells and consequently impairs optic cup formation. Overall, this study illustrates how spatiotemporal coordination between morphogenic movements and fate determination critically influences organogenesis. |
|
Icha J, Weber M, Waters JC, Norden C
|
Phototoxicity in live fluorescence microscopy, and how to avoid it.
|
Bioessays. 2017 Aug;39(8)
|
|
Imaging Technologies Development
|

|
28749075 |
light sheet fluorescence microscopy; live imaging; photobleaching; photodamage; phototoxicity; reactive oxygen species; selective plane illumination |
Phototoxicity frequently occurs during live fluorescence microscopy, and its consequences are often underestimated. Damage to cellular macromolecules upon excitation light illumination can impair sample physiology, and even lead to sample death. In this review, we explain how phototoxicity influences live samples, and we highlight that, besides the obvious effects of phototoxicity, there are often subtler consequences of illumination that are imperceptible when only the morphology of samples is examined. Such less apparent manifestations of phototoxicity are equally problematic, and can change the conclusions drawn from an experiment. Thus, limiting phototoxicity is a prerequisite for obtaining reproducible quantitative data on biological processes. We present strategies to reduce phototoxicity, e.g. limiting the illumination to the focal plane and suggest controls for phototoxicity effects. Overall, we argue that phototoxicity needs increased attention from researchers when designing experiments, and when evaluating research findings. |
|
Stepanek L, Pigino G
|
Millisecond time resolution correlative light and electron microscopy for dynamic cellular processes.
|
Methods Cell Biol. 2017;140:1-20
|
|
Imaging Technologies Development
|

|
28528628 |
Chlamydomonas; Cilia; Electron tomography; Flagella; Intraflagellar transport; Microtubules; Molecular motors; TIRF microscopy; Time-resolved correlative light and electron microscopy |
Molecular motors propel cellular components at velocities up to microns per second with nanometer precision. Imaging techniques combining high temporal and spatial resolution are therefore indispensable to understand the cellular mechanics at the molecular level. For example, intraflagellar transport (IFT) trains constantly shuttle ciliary components between the base and tip of the eukaryotic cilium. 3-D electron microscopy has revealed IFT train morphology and position, but was unable to correlate these features with the direction of train movement. Here, we present the methodology required to combine live-cell imaging at millisecond frame rates with electron tomography. Using this approach, we were able to correlate the direction of movement of every IFT train in a flagellum with its morphology and microtubule track. The method is ready to be further adapted for other experimental systems, including studies of single molecule dynamics. |
|
Stückemann T, Cleland JP, Werner S, Thi-Kim Vu H, Bayersdorf R, Liu SY, Friedrich B, Jülicher F, Rink JC
|
Antagonistic Self-Organizing Patterning Systems Control Maintenance and Regeneration of the Anteroposterior Axis in Planarians.
|
Dev Cell. 2017 Feb 6;40(3):248-263.e4
|
|
Developmental Biology
|

|
28171748 |
Turing pattern; Wnt signaling; morphogen gradient; patterning; planaria; regeneration; self-organization |
Planarian flatworms maintain their body plan in the face of constant internal turnover and can regenerate from arbitrary tissue fragments. Both phenomena require self-maintaining and self-organizing patterning mechanisms, the molecular mechanisms of which remain poorly understood. We show that a morphogenic gradient of canonical Wnt signaling patterns gene expression along the planarian anteroposterior (A/P) axis. Our results demonstrate that gradient formation likely occurs autonomously in the tail and that an autoregulatory module of Wnt-mediated Wnt expression both shapes the gradient at steady state and governs its re-establishment during regeneration. Functional antagonism between the tail Wnt gradient and an unknown head patterning system further determines the spatial proportions of the planarian A/P axis and mediates mutually exclusive molecular fate choices during regeneration. Overall, our results suggest that the planarian A/P axis is patterned by self-organizing patterning systems deployed from either end that are functionally coupled by mutual antagonism. |
|
Meyer K, Ostrenko O, Bourantas G, Morales-Navarrete H, Porat-Shliom N, Segovia-Miranda F, Nonaka H, Ghaemi A, Verbavatz JM, Brusch L, Sbalzarini I, Kalaidzidis Y, Weigert R, Zerial M
|
A Predictive 3D Multi-Scale Model of Biliary Fluid Dynamics in the Liver Lobule.
|
Cell Syst. 2017 Mar 22;4(3):277-290.e9
|
|
Cell Biology
|

|
28330614 |
acetaminophen; actomyosin contractility; bile canaliculi; bile flow; cholestasis; computational fluid dynamics; drug-induced liver injury; mouse liver; multi-scale model; peristalsis |
Bile, the central metabolic product of the liver, is transported by the bile canaliculi network. The impairment of bile flow in cholestatic liver diseases has urged a demand for insights into its regulation. Here, we developed a predictive 3D multi-scale model that simulates fluid dynamic properties successively from the subcellular to the tissue level. The model integrates the structure of the bile canalicular network in the mouse liver lobule, as determined by high-resolution confocal and serial block-face scanning electron microscopy, with measurements of bile transport by intravital microscopy. The combined experiment-theory approach revealed spatial heterogeneities of biliary geometry and hepatocyte transport activity. Based on this, our model predicts gradients of bile velocity and pressure in the liver lobule. Validation of the model predictions by pharmacological inhibition of Rho kinase demonstrated a requirement of canaliculi contractility for bile flow in vivo. Our model can be applied to functionally characterize liver diseases and quantitatively estimate biliary transport upon drug-induced liver injury. |
|
Joseph SR, Pálfy M, Hilbert L, Kumar M, Karschau J, Zaburdaev V, Shevchenko A, Vastenhouw NL
|
Competition between histone and transcription factor binding regulates the onset of transcription in zebrafish embryos.
|
Elife. 2017 Apr 20;6. pii: e23326
|
|
Developmental Biology
|

|
28425915 |
ZGA; chromosomes; competition; developmental biology; embryogenesis; genes; histones; stem cells; transcription regulation; zebrafish |
Upon fertilization, the genome of animal embryos remains transcriptionally inactive until the maternal-to-zygotic transition. At this time, the embryo takes control of its development and transcription begins. How the onset of zygotic transcription is regulated remains unclear. Here, we show that a dynamic competition for DNA binding between nucleosome-forming histones and transcription factors regulates zebrafish genome activation. Taking a quantitative approach, we found that the concentration of non-DNA-bound core histones sets the time for the onset of transcription. The reduction in nuclear histone concentration that coincides with genome activation does not affect nucleosome density on DNA, but allows transcription factors to compete successfully for DNA binding. In agreement with this, transcription factor binding is sensitive to histone levels and the concentration of transcription factors also affects the time of transcription. Our results demonstrate that the relative levels of histones and transcription factors regulate the onset of transcription in the embryo. |
|
Anitei M, Stange C, Czupalla C, Niehage C, Schuhmann K, Sala P, Czogalla A, Pursche T, Coskun Ü, Shevchenko A, Hoflack B
|
Spatiotemporal Control of Lipid Conversion, Actin-Based Mechanical Forces, and Curvature Sensors during Clathrin/AP-1-Coated Vesicle Biogenesis.
|
Cell Rep. 2017 Aug 29;20(9):2087-2099
|
|
Cell Biology
|
|
28854360 |
AP-1; PI[4,5]P2; arfaptin; clathrin; diacylglycerol; mannose-6-phosphate receptor; trans-Golgi network; transport carrier |
Clathrin/adaptor protein-1-coated carriers connect the secretory and the endocytic pathways. Carrier biogenesis relies on distinct protein networks changing membrane shape at the trans-Golgi network, each regulating coat assembly, F-actin-based mechanical forces, or the biophysical properties of lipid bilayers. How these different hubs are spatiotemporally coordinated remains largely unknown. Using in vitro reconstitution systems, quantitative proteomics, and lipidomics, as well as in vivo cell-based assays, we characterize the protein networks controlling membrane lipid composition, membrane shape, and carrier scission. These include PIP5K1A and phospholipase C-beta 3 controlling the conversion of PI[4]P into diacylglycerol. PIP5K1A binding to RAC1 provides a link to F-actin-based mechanical forces needed to tubulate membranes. Tubular membranes then recruit the BAR-domain-containing arfaptin-1/2 guiding carrier scission. These findings provide a framework for synchronizing the chemical/biophysical properties of lipid bilayers, F-actin-based mechanical forces, and the activity of proteins sensing membrane shape during clathrin/adaptor protein-1-coated carrier biogenesis. |
|
Tang TD, Cecchi D, Fracasso G, Accardi D, Coutable-Pennarun A, Mansy SS, Perriman AW, Anderson JLR, Mann S
|
Gene-Mediated Chemical Communication in Synthetic Protocell Communities.
|
ACS Synth Biol. 2017 Nov 8
|
|
Cell Biology
|

|
29091420 |
cell-free expression; communication; enzyme cascade; genetic switches; lipid vesicles; proteinosomes; α-hemolysin |
A gene-directed chemical communication pathway between synthetic protocell signaling transmitters (lipid vesicles) and receivers (proteinosomes) was designed, built and tested using a bottom-up modular approach comprising small molecule transcriptional control, cell-free gene expression, porin-directed efflux, substrate signaling, and enzyme cascade-mediated processing. |
|
Viktorinová I, Henry I, Tomancak P
|
Epithelial rotation is preceded by planar symmetry breaking of actomyosin and protects epithelial tissue from cell deformations.
|
PLoS Genet. 2017 Nov 27;13(11):e1007107
|
|
Developmental Biology
|

|
29176774 |
|
Symmetry breaking is involved in many developmental processes that form bodies and organs. One of them is the epithelial rotation of developing tubular and acinar organs. However, how epithelial cells move, how they break symmetry to define their common direction, and what function rotational epithelial motions have remains elusive. Here, we identify a dynamic actomyosin network that breaks symmetry at the basal surface of the Drosophila follicle epithelium of acinar-like primitive organs, called egg chambers, and may represent a candidate force-generation mechanism that underlies the unidirectional motion of this epithelial tissue. We provide evidence that the atypical cadherin Fat2, a key planar cell polarity regulator in Drosophila oogenesis, directs and orchestrates transmission of the intracellular actomyosin asymmetry cue onto a tissue plane in order to break planar actomyosin symmetry, facilitate epithelial rotation in the opposite direction, and direct the elongation of follicle cells. In contrast, loss of this rotational motion results in anisotropic non-muscle Myosin II pulses that are disorganized in plane and causes cell deformations in the epithelial tissue of Drosophila eggs. Our work demonstrates that atypical cadherins play an important role in the control of symmetry breaking of cellular mechanics in order to facilitate tissue motion and model epithelial tissue. We propose that their functions may be evolutionarily conserved in tubular/acinar vertebrate organs. |
|
Richter S, Schulze U, Tomançak P, Oates AC
|
Small molecule screen in embryonic zebrafish using modular variations to target segmentation.
|
Nat Commun. 2017 Dec 1;8(1):1901
|
|
Developmental Biology
|

|
29196645 |
|
Small molecule in vivo phenotypic screening is used to identify drugs or biological activities by directly assessing effects in intact organisms. However, current screening designs may not exploit the full potential of chemical libraries due to false negatives. Here, we demonstrate a modular small molecule screen in embryonic zebrafish that varies concentration, genotype and timing to target segmentation disorders, birth defects that affect the spinal column. By testing each small molecule in multiple interrelated ways, this screen recovers compounds that a standard screening design would have missed, increasing the hit frequency from the chemical library three-fold. We identify molecular pathways and segmentation phenotypes, which we share in an open-access annotated database. These hits provide insight into human vertebral segmentation disorders and myopathies. This modular screening strategy is applicable to other developmental questions and disease models, highlighting the power of relatively small chemical libraries to accelerate gene discovery and disease study. |
|
Stapel LC, Zechner C, Vastenhouw NL
|
Uniform gene expression in embryos is achieved by temporal averaging of transcription noise.
|
Genes Dev. 2017 Aug 15;31(16):1635-1640
|
|
Developmental Biology
|

|
28903980 |
ZGA; smFISH; stochastic transcription; uniform expression; zebrafish |
Transcription is often stochastic. This is seemingly incompatible with the importance of gene expression during development. Here we show that during zebrafish embryogenesis, transcription activation is stochastic due to (1) genes acquiring transcriptional competence at different times in different cells, (2) differences in cell cycle stage between cells, and (3) the stochastic nature of transcription. Initially, stochastic transcription causes large cell-to-cell differences in transcript levels. However, variability is reduced by lengthening cell cycles and the accumulation of transcription events in each cell. Temporal averaging might provide a general context in which to understand how embryos deal with stochastic transcription. |
|
Zeigerer A, Wuttke A, Marsico G, Seifert S, Kalaidzidis Y, Zerial M
|
Functional properties of hepatocytes in vitro are correlated with cell polarity maintenance.
|
Exp Cell Res. 2017 Jan 1;350(1):242-252
|
|
Cell Biology
|

|
27916608 |
Cell polarity; Endocytosis; Liver; Metabolism; Primary hepatocyte cultures |
Exploring the cell biology of hepatocytes in vitro could be a powerful strategy to dissect the molecular mechanisms underlying the structure and function of the liver in vivo. However, this approach relies on appropriate in vitro cell culture systems that can recapitulate the cell biological and metabolic features of the hepatocytes in the liver whilst being accessible to experimental manipulations. Here, we adapted protocols for high-resolution fluorescence microscopy and quantitative image analysis to compare two primary hepatocyte culture systems, monolayer and collagen sandwich, with respect to the distribution of two distinct populations of early endosomes (APPL1 and EEA1-positive), endocytic capacity, metabolic and signaling activities. In addition to the re-acquisition of hepatocellular polarity, primary hepatocytes grown in collagen sandwich but not in monolayer culture recapitulated the apico-basal distribution of EEA1 endosomes observed in liver tissue. We found that such distribution correlated with the organization of the actin cytoskeleton in vitro and, surprisingly, was dependent on the nutritional state in vivo. Hepatocytes in collagen sandwich also exhibited faster kinetics of low-density lipoprotein (LDL) and epidermal growth factor (EGF) internalization, showed improved insulin sensitivity and preserved their ability for glucose production, compared to hepatocytes in monolayer cultures. Although no in vitro culture system can reproduce the exquisite structural features of liver tissue, our data nevertheless highlight the ability of the collagen sandwich system to recapitulate key structural and functional properties of the hepatocytes in the liver and, therefore, support the usage of this system to study aspects of hepatocellular biology in vitro. |
|
Müller A, Neukam M, Ivanova A, Sönmez A, Münster C, Kretschmar S, Kalaidzidis Y, Kurth T, Verbavatz JM, Solimena M
|
A Global Approach for Quantitative Super Resolution and Electron Microscopy on Cryo and Epoxy Sections Using Self-labeling Protein Tags.
|
Sci Rep. 2017 Feb 2;7(1):23
|
- LMF MPI-CBG
- EMF & Histo CMCB
- EMF MPI-CBG
|
Imaging Technologies Development
|

|
28154417 |
|
Correlative light and electron microscopy (CLEM) is a powerful approach to investigate the molecular ultrastructure of labeled cell compartments. However, quantitative CLEM studies are rare, mainly due to small sample sizes and the sensitivity of fluorescent proteins to strong fixatives and contrasting reagents for EM. Here, we show that fusion of a self-labeling protein to insulin allows for the quantification of age-distinct insulin granule pools in pancreatic beta cells by a combination of super resolution and transmission electron microscopy on Tokuyasu cryosections. In contrast to fluorescent proteins like GFP organic dyes covalently bound to self-labeling proteins retain their fluorescence also in epoxy resin following high pressure freezing and freeze substitution, or remarkably even after strong chemical fixation. This enables for the assessment of age-defined granule morphology and degradation. Finally, we demonstrate that this CLEM protocol is highly versatile, being suitable for single and dual fluorescent labeling and detection of different proteins with optimal ultrastructure preservation and contrast. |
|
Ahmed Alfar E, Kirova D, Konantz J, Birke S, Mansfeld J, Ninov N
|
Distinct Levels of Reactive Oxygen Species Coordinate Metabolic Activity with Beta-cell Mass Plasticity.
|
Sci Rep. 2017 Jun 26;7(1):3994
|
|
Medical Biology
|

|
28652605 |
|
The pancreatic beta-cells control glucose homeostasis by secreting insulin in response to nutrient intake. The number of beta-cells is under tight metabolic control, as this number increases with higher nutrient intake. However, the signaling pathways matching nutrition with beta-cell mass plasticity remain poorly defined. By applying pharmacological and genetic manipulations, we show that reactive oxygen species (ROS) regulate dose-dependently beta-cell proliferation in vivo and in vitro. In particular, reducing ROS levels in beta-cells blocks their proliferation in response to nutrients. Using a non-invasive genetic sensor of intracellular hydrogen peroxide (H2O2), we reveal that glucose can directly increase the levels of H2O2. Furthermore, a moderate increase in H2O2 levels can stimulate beta-cell proliferation. Interestingly, while high H2O2 levels are inhibitory to beta-cell proliferation, they expand beta-cell mass in vivo by inducing rapid beta-cell neogenesis. Our study thus reveals a ROS-level-dependent mechanism linking nutrients with beta-cell mass plasticity. Hence, given the requirement of ROS for beta-cell mass expansion, antioxidant therapies should be applied with caution in diabetes. |
|
Schwarzer S, Spieß S, Brand M, Hans S
|
Dlx3b/4b is required for early-born but not later-forming sensory hair cells during zebrafish inner ear development.
|
Biol Open. 2017 Sep 15;6(9):1270-1278
|
|
Developmental Biology
|

|
28751305 |
CRISPR/Cas9; Dlx3b/4b; Foxi1; Inner ear; Neurogenesis; Sensorigenesis; Tether cells; Zebrafish |
Morpholino-mediated knockdown has shown that the homeodomain transcription factors Dlx3b and Dlx4b are essential for proper induction of the otic-epibranchial progenitor domain (OEPD), as well as subsequent formation of sensory hair cells in the developing zebrafish inner ear. However, increasing use of reverse genetic approaches has revealed poor correlation between morpholino-induced and mutant phenotypes. Using CRISPR/Cas9-mediated mutagenesis, we generated a defined deletion eliminating the entire open reading frames of dlx3b and dlx4b (dlx3b/4b) and investigated a potential phenotypic difference between mutants and morpholino-mediated knockdown. Consistent with previous findings obtained by morpholino-mediated knockdown of Dlx3b and Dlx4b, dlx3b/4b mutants display compromised otic induction, the development of smaller otic vesicles and an elimination of all indications of otic specification when combined with loss of foxi1, a second known OEPD competence factor in zebrafish. Furthermore, sensorigenesis is also affected in dlx3b/4b mutants. However, we find that only early-born sensory hair cells (tether cells), that seed and anchor the formation of otoliths, are affected. Later-forming sensory hair cells are present, indicating that two genetically distinct pathways control the development of early-born and later-forming sensory hair cells. Finally, impairment of early-born sensory hair cell formation in dlx3b/4b mutant embryos reverses the common temporal sequence of neuronal and sensory hair cell specification in zebrafish, resembling the order of cell specification in amniotes; Neurog1 expression before Atoh1 expression. We conclude that the Dlx3b/4b-dependent pathway has been either acquired newly in the fish lineage or lost in other vertebrate species during evolution, and that the events during early inner ear development are remarkably similar in fish and amniotes in the absence of this pathway. |
|
Singh SP, Janjuha S, Hartmann T, Kayisoglu Ö, Konantz J, Birke S, Murawala P, Alfar EA, Murata K, Eugster A, Tsuji N, Morrissey ER, Brand M, Ninov N
|
Different developmental histories of beta-cells generate functional and proliferative heterogeneity during islet growth.
|
Nat Commun. 2017 Sep 22;8(1):664
|
|
Developmental Biology
|

|
28939870 |
|
The proliferative and functional heterogeneity among seemingly uniform cells is a universal phenomenon. Identifying the underlying factors requires single-cell analysis of function and proliferation. Here we show that the pancreatic beta-cells in zebrafish exhibit different growth-promoting and functional properties, which in part reflect differences in the time elapsed since birth of the cells. Calcium imaging shows that the beta-cells in the embryonic islet become functional during early zebrafish development. At later stages, younger beta-cells join the islet following differentiation from post-embryonic progenitors. Notably, the older and younger beta-cells occupy different regions within the islet, which generates topological asymmetries in glucose responsiveness and proliferation. Specifically, the older beta-cells exhibit robust glucose responsiveness, whereas younger beta-cells are more proliferative but less functional. As the islet approaches its mature state, heterogeneity diminishes and beta-cells synchronize function and proliferation. Our work illustrates a dynamic model of heterogeneity based on evolving proliferative and functional beta-cell states.Βeta-cells have recently been shown to be heterogeneous with regard to morphology and function. Here, the authors show that β-cells in zebrafish switch from proliferative to functional states with increasing time since β-cell birth, leading to functional and proliferative heterogeneity. |
|
Zerjatke T, Gak IA, Kirova D, Fuhrmann M, Daniel K, Gonciarz M, Müller D, Glauche I, Mansfeld J
|
Quantitative Cell Cycle Analysis Based on an Endogenous All-in-One Reporter for Cell Tracking and Classification.
|
Cell Rep. 2017 May 30;19(9):1953-1966.
|
|
Cell Biology
|
|
28564611 |
G1 phase regulation; automated image analysis; cell cycle; cell cycle reporter; cell fate decisions; cyclin D1; cyclin oscillations; p21; quantitative single cell imaging; quiescence |
Cell cycle kinetics are crucial to cell fate decisions. Although live imaging has provided extensive insights into this relationship at the single-cell level, the limited number of fluorescent markers that can be used in a single experiment has hindered efforts to link the dynamics of individual proteins responsible for decision making directly to cell cycle progression. Here, we present fluorescently tagged endogenous proliferating cell nuclear antigen (PCNA) as an all-in-one cell cycle reporter that allows simultaneous analysis of cell cycle progression, including the transition into quiescence, and the dynamics of individual fate determinants. We also provide an image analysis pipeline for automated segmentation, tracking, and classification of all cell cycle phases. Combining the all-in-one reporter with labeled endogenous cyclin D1 and p21 as prime examples of cell-cycle-regulated fate determinants, we show how cell cycle and quantitative protein dynamics can be simultaneously extracted to gain insights into G1 phase regulation and responses to perturbations. |
|
Albert EA, Bökel C
|
A cell based, high throughput assay for quantitative analysis of Hedgehog pathway activation using a Smoothened activation sensor.
|
Sci Rep. 2017 Oct 30;7(1):14341
|
|
Cell Biology
|

|
29085027 |
|
The Hedgehog (Hh) signalling cascade plays an important role in development and disease. In the absence of Hh ligand, activity of the key signal transducer Smoothened (Smo) is downregulated by the Hh receptor Patched (Ptc). However, the mechanisms underlying this inhibition, and especially its release upon ligand stimulation, are still poorly understood, in part because tools for following Smo activation at the subcellular level were long lacking. To address this deficit we have developed a high throughput cell culture assay based on a fluorescent sensor for Drosophila Smo activation. We have screened a small molecule inhibitor library, and observed increased Smo sensor fluorescence with compounds aimed at two major target groups, the MAPK signalling cascade and polo and aurora kinases. Biochemical validation for selected inhibitors (dobrafenib, tak-733, volasertib) confirmed the screen results and revealed differences in the mode of Smo activation. Furthermore, monitoring Smo activation at the single cell level indicated that individual cells exhibit different threshold responses to Hh stimulation, which may be mechanistically relevant for the formation of graded Hh responses. Together, these results thus provide proof of principle that our assay may become a valuable tool for dissecting the cell biological basis of Hh pathway activation. |
|
Kesavan G, Chekuru A, Machate A, Brand M
|
CRISPR/Cas9-Mediated Zebrafish Knock-in as a Novel Strategy to Study Midbrain-Hindbrain Boundary Development.
|
Front Neuroanat. 2017 Jun 30;11:52
|
|
Developmental Biology
|

|
28713249 |
CRISPR/Cas9; knock-in reporter; midbrain-hindbrain boundary (MHB); zebrafish and transgenesis |
The midbrain-hindbrain boundary (MHB) acts as an organizer and controls the fate of neighboring cells to develop into either mesencephalic (midbrain) or metencephalic (hindbrain) cells by secreting signaling molecules like Wnt1 and Fgf8. The zebrafish is an excellent vertebrate model for studying MHB development due to the ease of gene manipulation and the possibility of following cellular dynamics and morphogenetic processes using live imaging. Currently, only very few reporter and/or Cre-driver lines are available to study gene expression at the MHB, hampering the understanding of MHB development, and traditional transgenic technologies using promoter/enhancer fragments or bacterial artificial chromosome (BAC)-mediated transgenesis often do not faithfully recapitulate endogenous expression patterns. In contrast, CRISPR/Cas9-mediated genome editing technology now provides a great opportunity to efficiently knock-in or knock-out genes. We have generated four CRISPR/Cas9-based knock-in fluorescent reporter lines for two crucial genes involved in MHB development, namely otx2 and pax2a. The coding sequences of the reporters were knocked-in upstream of the corresponding ATG and are, thus, under the control of the endogenous promoter/enhancer elements. Interestingly, this strategy does not disturb endogenous gene expression. Using the fast maturing fluorescent protein reporter, Venus, enabled us to follow MHB development using cell tracking and live imaging. In addition, we show that these reporter lines label various neuronal and glial cell types in the adult zebrafish brain, making them highly suitable for investigating embryonic and adult midbrain, hindbrain, and MHB development. |
|
Klapper SD, Sauter EJ, Swiersy A, Hyman MAE, Bamann C, Bamberg E, Busskamp V
|
On-demand optogenetic activation of human stem-cell-derived neurons.
|
Sci Rep. 2017 Oct 31;7(1):14450
|
|
Medical Biology
|

|
29089561 |
|
The widespread application of human stem-cell-derived neurons for functional studies is impeded by complicated differentiation protocols, immaturity, and deficient optogene expression as stem cells frequently lose transgene expression over time. Here we report a simple but precise Cre-loxP-based strategy for generating conditional, and thereby stable, optogenetic human stem-cell lines. These cells can be easily and efficiently differentiated into functional neurons, and optogene expression can be triggered by administering Cre protein to the cultures. This conditional expression system may be applied to stem-cell-derived neurons whenever timed transgene expression could help to overcome silencing at the stem-cell level. |
|
Schäfer P, Karl MO
|
Prospective purification and characterization of Müller glia in the mouse retina regeneration assay.
|
Glia. 2017 May;65(5):828-847
|
|
Cell Biology
|

|
28220544 |
Müller glia; gliosis; regeneration; retina; stem cell |
Reactive gliosis is an umbrella term for various glia functions in neurodegenerative diseases and upon injury. Specifically, Müller glia (MG) in some species readily regenerate retinal neurons to restore vision loss after insult, whereas mammalian MG respond by reactive gliosis-a heterogeneous response which frequently includes cell hypertrophy and proliferation. Limited regeneration has been stimulated in mammals, with a higher propensity in young MG, and in vitro compared to in vivo, but the underlying processes are unknown. To facilitate studies on the mechanisms regulating and limiting glia functions, we developed a strategy to purify glia and their progeny by fluorescence-activated cell sorting. Dual-transgenic nuclear reporter mice, which label neurons and glia with red and green fluorescent proteins, respectively, have enabled MG enrichment up to 93% purity. We applied this approach to MG in a mouse retina regeneration ex vivo assay. Combined cell size and cell cycle analysis indicates that most MG hypertrophy and a subpopulation proliferates which, over time, become even larger in cell size than the ones that do not proliferate. MG undergo timed differential genomic changes in genes controlling stemness and neurogenic competence; and glial markers are downregulated. Genes that are potentially required for, or associated with, regeneration and reactive gliosis are differentially regulated by retina explant culture time, epidermal growth factor stimulation, and animal age. Thus, MG enrichment facilitates cellular and molecular studies which, in combination with the mouse retina regeneration assay, provide an experimental approach for deciphering mechanisms that possibly regulate reactive gliosis and limit regeneration in mammals. |
|
Sardar Pasha SPB, Münch R, Schäfer P, Oertel P, Sykes AM, Zhu Y, Karl MO
|
Retinal cell death dependent reactive proliferative gliosis in the mouse retina.
|
Sci Rep. 2017 Aug 25;7(1):9517
|
|
Cell Biology
|

|
28842607 |
|
Neurodegeneration is a common starting point of reactive gliosis, which may have beneficial and detrimental consequences. It remains incompletely understood how distinctive pathologies and cell death processes differentially regulate glial responses. Müller glia (MG) in the retina are a prime model: Neurons are regenerated in some species, but in mammals there may be proliferative disorders and scarring. Here, we investigated the relationship between retinal damage and MG proliferation, which are both induced in a reproducible and temporal order in organotypic culture of EGF-treated mouse retina: Hypothermia pretreatment during eye dissection reduced neuronal cell death and MG proliferation; stab wounds increased both. Combined (but not separate) application of defined cell death signaling pathway inhibitors diminished neuronal cell death and maintained MG mitotically quiescent. The level of neuronal cell death determined MG activity, indicated by extracellular signal-regulated kinase (ERK) phosphorylation, and proliferation, both of which were abolished by EGFR inhibition. Our data suggest that retinal cell death, possibly either by programmed apoptosis or necrosis, primes MG to be able to transduce the EGFR-ERK activity required for cell proliferation. These results imply that cell death signaling pathways are potential targets for future therapies to prevent the proliferative gliosis frequently associated with certain neurodegenerative conditions. |
|
Bhattarai P, Thomas AK, Zhang Y, Kizil C
|
The effects of aging on Amyloid-β42-induced neurodegeneration and regeneration in adult zebrafish brain.
|
Neurogenesis (Austin). 2017 May 2;4(1):e1322666
|
|
Neurobiology
|

|
28656156 |
Alzheimer disease; Aβ42; aging; amyloid-β 42; inflammation; microglia; neural stem progenitor cell; neurodegeneration; neurogenesis; regeneration; zebrafish |
Alzheimer disease is the most prevalent neurodegenerative disease and is associated with aggregation of Amyloid-β42 peptides. In mammals, Amyloid-β42 causes impaired neural stem/progenitor cell (NSPC) proliferation and neurogenesis, which exacerbate with aging. The molecular programs necessary to enhance NSPC proliferation and neurogenesis in our brains to mount successful regeneration are largely unknown. Therefore, to identify the molecular basis of effective brain regeneration, we previously established an Amyloid-β42 model in adult zebrafish that displayed Alzheimer-like phenotypes reminiscent of humans. Interestingly, zebrafish exhibited enhanced NSPC proliferation and neurogenesis after microinjection of Amyloid-β42 peptide. Here, we compare old and young fish to address the effects of aging on regenerative ability after Amyloid-β42 deposition. We found that aging does not affect the rate of NSPC proliferation but reduces the neurogenic response and microglia/macrophage activation after microinjection of Amyloid-β42 in zebrafish, suggesting an important link between aging, neuroinflammation, regenerative neurogenesis and neural stem cell plasticity. |
|
Bhattarai P, Thomas AK, Cosacak MI, Papadimitriou C, Mashkaryan V, Zhang Y, Kizil C
|
Modeling Amyloid-β42 Toxicity and Neurodegeneration in Adult Zebrafish Brain.
|
J Vis Exp. 2017 Oct 25;(128)
|
|
Neurobiology
|
|
29155703 |
|
Alzheimer's disease (AD) is a debilitating neurodegenerative disease in which accumulation of toxic amyloid-β42 (Aβ42) peptides leads to synaptic degeneration, inflammation, neuronal death, and learning deficits. Humans cannot regenerate lost neurons in the case of AD in part due to impaired proliferative capacity of the neural stem/progenitor cells (NSPCs) and reduced neurogenesis. Therefore, efficient regenerative therapies should also enhance the proliferation and neurogenic capacity of NSPCs. Zebrafish (Danio rerio) is a regenerative organism, and we can learn the basic molecular programs with which we could design therapeutic approaches to tackle AD. For this reason, the generation of an AD-like model in zebrafish was necessary. Using our methodology, we can introduce synthetic derivatives of Aβ42 peptide with tissue penetrating capability into the adult zebrafish brain, and analyze the disease pathology and the regenerative response. The advantage over the existing methods or animal models is that zebrafish can teach us how a vertebrate brain can naturally regenerate, and thus help us to treat human neurodegenerative diseases better by targeting endogenous NSPCs. Therefore, the amyloid-toxicity model established in the adult zebrafish brain may open new avenues for research in the field of neuroscience and clinical medicine. Additionally, the simple execution of this method allows for cost-effective and efficient experimental assessment. This manuscript describes the synthesis and injection of Aβ42 peptides into zebrafish brain. |
|
Kroehne V, Tsata V, Marrone L, Froeb C, Reinhardt S, Gompf A, Dahl A, Sterneckert J, Reimer MM
|
Primary Spinal OPC Culture System from Adult Zebrafish to Study Oligodendrocyte Differentiation In Vitro.
|
Front Cell Neurosci. 2017 Sep 14;11:284
|
|
Neurobiology
|

|
28959189 |
OL; OPC; adult zebrafish; human motor neuron; oligodendrocyte progenitor cell; primary OPC culture; remyelination; spinal cord injury |
Endogenous oligodendrocyte progenitor cells (OPCs) are a promising target to improve functional recovery after spinal cord injury (SCI) by remyelinating denuded, and therefore vulnerable, axons. Demyelination is the result of a primary insult and secondary injury, leading to conduction blocks and long-term degeneration of the axons, which subsequently can lead to the loss of their neurons. In response to SCI, dormant OPCs can be activated and subsequently start to proliferate and differentiate into mature myelinating oligodendrocytes (OLs). Therefore, researchers strive to control OPC responses, and utilize small molecule screening approaches in order to identify mechanisms of OPC activation, proliferation, migration and differentiation. In zebrafish, OPCs remyelinate axons of the optic tract after lysophosphatidylcholine (LPC)-induced demyelination back to full thickness myelin sheaths. In contrast to zebrafish, mammalian OPCs are highly vulnerable to excitotoxic stress, a cause of secondary injury, and remyelination remains insufficient. Generally, injury induced remyelination leads to shorter internodes and thinner myelin sheaths in mammals. In this study, we show that myelin sheaths are lost early after a complete spinal transection injury, but are re-established within 14 days after lesion. We introduce a novel, easy-to-use, inexpensive and highly reproducible OPC culture system based on dormant spinal OPCs from adult zebrafish that enables in vitro analysis. Zebrafish OPCs are robust, can easily be purified with high viability and taken into cell culture. This method enables to examine why zebrafish OPCs remyelinate better than their mammalian counterparts, identify cell intrinsic responses, which could lead to pro-proliferating or pro-differentiating strategies, and to test small molecule approaches. In this methodology paper, we show efficient isolation of OPCs from adult zebrafish spinal cord and describe culture conditions that enable analysis up to 10 days in vitro. Finally, we demonstrate that zebrafish OPCs differentiate into Myelin Basic Protein (MBP)-expressing OLs when co-cultured with human motor neurons differentiated from induced pluripotent stem cells (iPSCs). This shows that the basic mechanisms of oligodendrocyte differentiation are conserved across species and that understanding the regulation of zebrafish OPCs can contribute to the development of new treatments to human diseases. |
|
Gonçalves DPN, Rodriguez RD, Kurth T, Bray LJ, Binner M, Jungnickel C, Gür FN, Poser SW, Schmidt TL, Zahn DRT, Androutsellis-Theotokis A, Schlierf M, Werner C
|
Enhanced targeting of invasive glioblastoma cells by peptide-functionalized gold nanorods in hydrogel-based 3D cultures.
|
Acta Biomater. 2017 Aug;58:12-25
|
|
Medical Biology
|

|
28576716 |
3D culture; Cancer stem cells; Glioblastoma Multiforme; Gold nanorods; Photothermolysis |
Cancer stem cells (CSCs) are responsible for drug resistance, tumor recurrence, and metastasis in several cancer types, making their eradication a primary objective in cancer therapy. Glioblastoma Multiforme (GBM) tumors are usually composed of a highly infiltrating CSC subpopulation, which has Nestin as a putative marker. Since the majority of these infiltrating cells are able to elude conventional therapies, we have developed gold nanorods (AuNRs) functionalized with an engineered peptide capable of specific recognition and selective eradication of Nestin positive infiltrating GBM-CSCs. These AuNRs generate heat when irradiated by a near-infrared laser, and cause localized cell damage. Nanoparticle internalization assays performed with GBM-CSCs or Nestin negative cells cultured as two-dimensional (2D) monolayers or embedded in three-dimensional (3D) biodegradable-hydrogels of tunable mechanical properties, revealed that the AuNRs were mainly internalized by GBM-CSCs, and not by Nestin negative cells. The AuNRs were taken up via energy-dependent and caveolae-mediated endocytic mechanisms, and were localized inside endosomes. Photothermal treatments resulted in the selective elimination of GBM-CSCs through cell apoptosis, while Nestin negative cells remained viable. Results also indicated that GBM-CSCs embedded in hydrogels were more resistant to AuNR photothermal treatments than when cultured as 2D monolayers. In summary, the combination of our engineered AuNRs with our tunable hydrogel system has shown the potential to provide an in vitro platform for the evaluation and screening of AuNR-based cancer therapeutics, leading to a substantial advancement in the application of AuNRs for targeted GBM-CSC therapy.
STATEMENT OF SIGNIFICANCE:
There is an urgent need for reliable and efficient therapies for the treatment of Glioblastoma Multiforme (GBM), which is currently an untreatable brain tumor form with a very poor patient survival rate. GBM tumors are mostly comprised of cancer stem cells (CSCs), which are responsible for tumor reoccurrence and therapy resistance. We have developed gold nanorods functionalized with an engineered peptide capable of selective recognition and eradication of GBM-CSCs via heat generation by nanorods upon NIR irradiation. An in vitro evaluation of nanorod therapeutic activities was performed in 3D synthetic-biodegradable hydrogel models with distinct biomechanical cues, and compared to 2D cultures. Results indicated that cells cultured in 3D were more resistant to photothermolysis than in 2D systems. |
|
Hofmann A, Peitzsch M, Brunssen C, Mittag J, Jannasch A, Frenzel A, Brown N, Weldon SM, Eisenhofer G, Bornstein SR, Morawietz H
|
Elevated Steroid Hormone Production in the db/db Mouse Model of Obesity and Type 2 Diabetes.
|
Horm Metab Res. 2017 Jan;49(1):43-49
|
|
Medical Biology
|
|
27813053 |
|
Obesity and type 2 diabetes have become a major public health problem worldwide. Steroid hormone dysfunction appears to be linked to development of obesity and type 2 diabetes and correction of steroid abnormalities may offer new approaches to therapy. We therefore analyzed plasma steroids in 15-16 week old obese and diabetic db/db mice using liquid chromatography-tandem mass spectrometry. Lean db/+ served as controls. Db/db mice developed obesity, hyperglycemia, hyperleptinemia, and hyperlipidemia. Hepatic triglyceride storage was increased and adiponectin and pancreatic insulin were lowered. Aldosterone, corticosterone, 11-deoxycorticosterone, and progesterone were respectively increased by 3.6-, 2.9-, 3.4, and 1.7-fold in db/db mice compared to controls. Ratios of aldosterone-to-progesterone and corticosterone-to-progesterone were respectively 2.0- and 1.5-fold higher in db/db mice. Genes associated with steroidogenesis were quantified in the adrenal glands and gonadal adipose tissues. In adrenals, Cyp11b2, Cyp11b1, Cyp21a1, Hsd3b1, Cyp11a1, and StAR were all significantly increased in db/db mice compared with db/+ controls. In adipose tissue, no Cyp11b2 or Cyp11b1 transcripts were detected and no differences in Cyp21a1, Hsd3b1, Cyp11a1, or StAR expression were found between db/+ and db/db mice. In conclusion, the present study showed an elevated steroid hormone production and adrenal steroidogenesis in the db/db model of obesity and type 2 diabetes. |
|
Taniguchi Y, Kurth T, Weiche S, Reichelt S, Tazaki A, Perike S, Kappert V, Epperlein HH
|
The posterior neural plate in axolotl gives rise to neural tube or turns anteriorly to form somites of the tail and posterior trunk.
|
Dev Biol. 2017 Feb 15;422(2):155-170
|
- EMF & Histo CMCB
- LMF & EMF CFCI
|
Developmental Biology
|

|
28017643 |
Anterior turn; Axolotl; Chordoneural hinge; Germ layer determination; Neural plate grafting; Posterior wall; Tailbud |
Classical grafting experiments in the Mexican axolotl had shown that the posterior neural plate of the neurula is no specified neuroectoderm but gives rise to somites of the tail and posterior trunk. The bipotentiality of this region with neuromesodermal progenitor cell populations was revealed more recently also in zebrafish, chick, and mouse. We reinvestigated the potency of the posterior plate in axolotl using grafts from transgenic embryos, immunohistochemistry, and in situ hybridization. The posterior plate is brachyury-positive except for its more anterior parts which express sox2. Between anterior and posterior regions of the posterior plate a small domain with sox2+ and bra+ cells exists. Lineage analysis of grafted GFP-labeled posterior plate tissue revealed that posterior GFP+ cells move from dorsal to ventral, form the posterior wall, turn anterior bilaterally, and join the gastrulated paraxial presomitic mesoderm. More anterior sox2+/GFP+ cells, however, are integrated into the developing spinal cord. Tail notochord is formed from axial mesoderm involuted already during gastrulation. Thus the posterior neural plate is a postgastrula source of paraxial mesoderm, which performs an anterior turn, a novel morphogenetic movement. More anterior plate cells, in contrast, do not turn anteriorly but become specified to form tail spinal cord. |
|
Schamel M, Bernhardt A, Quade M, Würkner C, Gbureck U, Moseke C, Gelinsky M, Lode A
|
Cu2+, Co2+ and Cr3+ doping of a calcium phosphate cement influences materials properties and response of human mesenchymal stromal cells.
|
Mater Sci Eng C Mater Biol Appl. 2017 Apr 1;73:99-110
|
|
Medical Biology
|

|
28183678 |
Brushite; Calcium phosphate cement; Chromium; Cobalt; Copper |
The application of biologically active metal ions to stimulate cellular reactions is a promising strategy to accelerate bone defect healing. Brushite-forming calcium phosphate cements were modified with low doses of Cu2+, Co2+ and Cr3+. The modified cements released the metal ions in vitro in concentrations which were shown to be non-toxic for cells. The release kinetics correlated with the solubility of the respective metal phosphates: 17-45 wt.-% of Co2+ and Cu2+, but <1 wt.-% of Cr3+ were released within 28days. Moreover, metal ion doping led to alterations in the exchange of calcium and phosphate ions with cell culture medium. In case of cements modified with 50mmol Cr3+/mol β-tricalcium phosphate (β-TCP), XRD and SEM analyses revealed a significant amount of monetite and a changed morphology of the cement matrix. Cell culture experiments with human mesenchymal stromal cells indicated that the observed cell response is not only influenced by the released metal ions but also by changed cement properties. A positive effect of modifications with 50mmol Cr3+ or 10mmol Cu2+ per mol β-TCP on cell behaviour was observed in indirect and direct culture. Modification with Co2+ resulted in a clear suppression of cell proliferation and osteogenic differentiation. In conclusion, metal ion doping of the cement influences cellular activities in addition to the effect of released metal ions by changing properties of the ceramic matrix. |
|
Akpınar M, Lesche M, Fanourgakis G, Fu J, Anastassiadis K, Dahl A, Jessberger R
|
TDRD6 mediates early steps of spliceosome maturation in primary spermatocytes.
|
PLoS Genet. 2017 Mar 6;13(3):e1006660
|
|
Cell Biology
|

|
28263986 |
|
Tudor containing protein 6 (TDRD6) is a male germ line-specific protein essential for chromatoid body (ChB) structure, elongated spermatid development and male fertility. Here we show that in meiotic prophase I spermatocytes TDRD6 interacts with the key protein arginine methyl transferase PRMT5, which supports splicing. TDRD6 also associates with spliceosomal core protein SmB in the absence of RNA and in an arginine methylation dependent manner. In Tdrd6-/- diplotene spermatocytes PRMT5 association with SmB and arginine dimethylation of SmB are much reduced. TDRD6 deficiency impairs the assembly of spliceosomes, which feature 3.5-fold increased levels of U5 snRNPs. In the nucleus, these deficiencies in spliceosome maturation correlate with decreased numbers of SMN-positive bodies and Cajal bodies involved in nuclear snRNP maturation. Transcriptome analysis of TDRD6-deficient diplotene spermatocytes revealed high numbers of splicing defects such as aberrant usage of intron and exons as well as aberrant representation of splice junctions. Together, this study demonstrates a novel function of TDRD6 in spliceosome maturation and mRNA splicing in prophase I spermatocytes. |
|
Al-Gburi S, Deussen AJ, Galli R, Muders MH, Zatschler B, Neisser A, Müller B, Kopaliani I
|
Sex-specific differences in age-dependent progression of aortic dysfunction and related cardiac remodeling in spontaneously hypertensive rats.
|
Am J Physiol Regul Integr Comp Physiol. 2017 May 1;312(5):R835-R849
|
|
Medical Biology
|
|
28274938 |
angiotensin type 2 receptor; aortic remodeling; cardiac remodeling; renin-angiotensin-system; sex characteristics |
Evidence of sex-specific differences in renin-angiotensin-system (RAS) and arterial pressure has been shown in many mammals, including spontaneously hypertensive rats (SHRs). Although SHRs have been used extensively as a leading experimental model of hypertension, the effects of sex-specific differences in RAS on aortic function and related cardiac remodeling during aging and hypertension have not been documented in detail. We examined structural and functional changes in aorta and heart of female and male SHRs at the ages of 5, 14, 29, and 36 wk. SHRs of both sexes were hypertensive from 14 wk. Aortic endothelial dysfunction and fibrosis, left ventricular (LV) hypertrophy, and cardiac fibrosis were evident at the age of 29 wk in male SHRs but first appeared only at the age of 36 wk in female SHRs. There was a pronounced delay of matrix metalloproteinase-2 activity in the aorta and heart of female SHRs, which was associated with preservation of 40% more elastin and less extensive cardiac fibrosis than in males. At 5, 29, and 36 wk of age, female SHRs showed higher levels of aortic and myocardial AT2R and MasR mRNA and decreased ANG II-mediated aortic constriction. Although female SHRs had increased relaxation to AT2R stimulation at 5 and 29 wk compared with males, this difference disappeared at 36 wk of age. This study documents sex-specific differences in the temporal progression of aortic dysfunction and LV hypertrophy in SHRs, which are independent of arterial pressure and are apparently mediated by higher AT2R expression in the heart and aorta of female SHRs. |
|
Quade M, Knaack S, Akkineni AR, Gabrielyan A, Lode A, Rösen-Wolff A, Gelinsky M
|
Central Growth Factor Loaded Depots in Bone Tissue Engineering Scaffolds for Enhanced Cell Attraction.
|
Tissue Eng Part A. 2017 Aug;23(15-16):762-772
|
|
Biomaterials
|

|
28316275 |
VEGF; alginate; collagen; endothelial cells; heparin; hyaluronic acid |
Tissue engineering, the application of stem and progenitor cells in combination with an engineered extracellular matrix, is a promising strategy for bone regeneration. However, its success is limited by the lack of vascularization after implantation. The concept of in situ tissue engineering envisages the recruitment of cells necessary for tissue regeneration from the host environment foregoing ex vivo cell seeding of the scaffold. In this study, we developed a novel scaffold system for enhanced cell attraction, which is based on biomimetic mineralized collagen scaffolds equipped with a central biopolymer depot loaded with chemotactic agents. In humid milieu, as after implantation, the signaling factors are expected to slowly diffuse out of the central depot forming a gradient that stimulates directed cell migration toward the scaffold center. Heparin, hyaluronic acid, and alginate have been shown to be capable of depot formation. By using vascular endothelial growth factor (VEGF) as model factor, it was demonstrated that the release kinetics can be adjusted by varying the depot composition. While alginate and hyaluronic acid are able to reduce the initial burst and prolong the release of VEGF, the addition of heparin led to a much stronger retention that resulted in an almost linear release over 28 days. The biological activity of released VEGF was proven for all variants using an endothelial cell proliferation assay. Furthermore, migration experiments with endothelial cells revealed a relationship between the degree of VEGF retention and migration distance: cells invaded deepest in scaffolds containing a heparin-based depot indicating that the formation of a steep gradient is crucial for cell attraction. In conclusion, this novel in situ tissue engineering approach, specifically designed to recruit and accommodate endogenous cells upon implantation, appeared highly promising to stimulate cell invasion, which in turn would promote vascularization and finally new bone formation. |
|
Mutsenko VV, Bazhenov VV, Rogulska O, Tarusin DN, Schütz K, Brüggemeier S, Gossla E, Akkineni AR, Meißner H, Lode A, Meschke S, Ehrlich A, Petović S, Martinović R, Djurović M, Stelling AL, Nikulin S, Rodin S, Tonevitsky A, Gelinsky M, Petrenko AY, Glasmacher B, Ehrlich H
|
3D chitinous scaffolds derived from cultivated marine demosponge Aplysina aerophoba for tissue engineering approaches based on human mesenchymal stromal cells.
|
Int J Biol Macromol. 2017 Nov;104(Pt B):1966-1974
|
|
Biomaterials
|

|
28347785 |
Chitin scaffolds; Mesenchymal stromal cells; Sponges |
The recently discovered chitin-based scaffolds derived from poriferans have the necessary prosperities for potential use in tissue engineering. Among the various demosponges of the Verongida order, Aplysina aerophoba is an attractive target for more in-depth investigations, as it is a renewable source of unique 3D microporous chitinous scaffolds. We found these chitinous scaffolds were cytocompatible and supported attachment, growth and proliferation of human mesenchymal stromal cells (hMSCs) in vitro. Cultivation of hMSCs on the scaffolds for 7days resulted in a two-fold increase in their metabolic activity, indicating increased cell numbers. Cells cultured onto chitin scaffolds in differentiation media were able to differentiate into the chondrogenic, adipogenic and osteogenic lineages, respectively. These results indicate A. aerophoba is a novel source of chitin scaffolds to futher hMSCs-based tissue engineering strategies. |
|
Mutsenko VV, Gryshkov O, Lauterboeck L, Rogulska O, Tarusin DN, Bazhenov VV, Schütz K, Brüggemeier S, Gossla E, Akkineni AR, Meißner H, Lode A, Meschke S, Fromont J, Stelling AL, Tabachnik KR, Gelinsky M, Nikulin S, Rodin S, Tonevitsky AG, Petrenko AY, Glasmacher B, Schupp PJ, Ehrlich H
|
Novel chitin scaffolds derived from marine sponge Ianthella basta for tissue engineering approaches based on human mesenchymal stromal cells: Biocompatibility and cryopreservation.
|
Int J Biol Macromol. 2017 Nov;104(Pt B):1955-1965
|
|
Biomaterials
|

|
28365291 |
Chitin; Marine sponges; Mesenchymal stromal cells; Scaffolds; Tissue engineering |
The extraordinary biocompatibility and mechanical properties of chitinous scaffolds from marine sponges endows these structures with unique properties that render them ideal for diverse biomedical applications. In the present work, a technological route to produce "ready-to-use" tissue-engineered products based on poriferan chitin is comprehensively investigated for the first time. Three key stages included isolation of scaffolds from the marine demosponge Ianthella basta, confirmation of their biocompatibility with human mesenchymal stromal cells, and cryopreservation of the tissue-like structures grown within these scaffolds using a slow cooling protocol. Biocompatibility of the macroporous, flat chitin scaffolds has been confirmed by cell attachment, high cell viability and the ability to differentiate into the adipogenic lineage. The viability of cells cryopreserved on chitin scaffolds was reduced by about 30% as compared to cells cryopreserved in suspension. However, the surviving cells were able to retain their differentiation potential; and this is demonstrated for the adipogenic lineage. The results suggest that chitin from the marine demosponge I. basta is a promising, highly biocompatible biomaterial for stem cell-based tissue-engineering applications. |
|
Al-Gburi S, Deussen A, Zatschler B, Weber S, Künzel S, El-Armouche A, Lorenz K, Cybularz M, Morawietz H, Kopaliani I
|
Sex-difference in expression and function of beta-adrenoceptors in macrovessels: role of the endothelium.
|
Basic Res Cardiol. 2017 May;112(3):29
|
|
Cell Biology
|

|
28389717 |
Beta-adrenoceptors; Human mammary artery; Sex-difference; Vascular endothelium; Vascular tone regulation |
Estrogen modulates adrenergic reactivity of macrovessels, resulting in weaker α-adrenergic vasoconstriction in females than males. However, the mechanisms governing this important sex-specific difference are not well understood. We hypothesized that vessels of females express more dilatory β-adrenoceptors, which counteract constrictive effects of α-adrenoceptors. This hypothesis was tested using aortas of normotensive (WKY) and hypertensive rats (SHR), along with human mammary artery. Selective blockade of β1 (CGP20712) or β3 (SR59230A), but not β2 (ICI118,551) adrenoceptors, greatly increased α-adrenergic constriction (norepinephrine) of aorta in female SHRs, but not in male SHRs at 12 weeks of age. Consistently, the selective β1/β2 (isoproterenol) and β3-adrenergic (BRL37344) relaxation was stronger in female SHRs than in males. Removal of endothelium and use of L-NMMA abolished sex-difference in α-adrenergic constriction and β-adrenergic relaxation. Immunostainings revealed endothelial localization of β1- and β3-adrenoceptors. mRNA levels of aortic β1- and β3-, but not β2-adrenoceptors were markedly higher in female than in male SHRs. The sex-specific differences in α-adrenergic constriction and β-adrenoceptor mRNA levels were age-dependent, predominantly present up to 29 weeks and disappeared at 36 weeks of age. The sex-specific difference was not strain-dependent and was similarly present in normotensive WKY rats. Human mammary artery of women showed a weaker α-adrenergic constriction than arteries of men. This sex-specific difference was prominent at 45-65 years and disappeared with aging. Our results convincingly demonstrate that female macrovessels express more dilatory β1- and β3-adrenoreceptors than male vessels with a predominant endothelial localization. This sex-specific difference is functionally relevant in young adults and is attenuated with aging |
|
Chung KJ, Chatzigeorgiou A, Economopoulou M, Garcia-Martin R, Alexaki VI, Mitroulis I, Nati M, Gebler J, Ziemssen T, Goelz SE, Phieler J, Lim JH, Karalis KP, Papayannopoulou T, Blüher M, Hajishengallis G, Chavakis T
|
A self-sustained loop of inflammation-driven inhibition of beige adipogenesis in obesity.
|
Nat Immunol. 2017 Jun;18(6):654-664
|
|
Medical Biology
|

|
28414311 |
|
In obesity, inflammation of white adipose tissue (AT) is associated with diminished generation of beige adipocytes ('beige adipogenesis'), a thermogenic and energy-dissipating function mediated by beige adipocytes that express the uncoupling protein UCP1. Here we delineated an inflammation-driven inhibitory mechanism of beige adipogenesis in obesity that required direct adhesive interactions between macrophages and adipocytes mediated by the integrin α4 and its counter-receptor VCAM-1, respectively; expression of the latter was upregulated in obesity. This adhesive interaction reciprocally and concomitantly modulated inflammatory activation of macrophages and downregulation of UCP1 expression dependent on the kinase Erk in adipocytes. Genetic or pharmacological inactivation of the integrin α4 in mice resulted in elevated expression of UCP1 and beige adipogenesis of subcutaneous AT in obesity. Our findings, established in both mouse systems and human systems, reveal a self-sustained cycle of inflammation-driven impairment of beige adipogenesis in obesity. |
|
Giebe S, Cockcroft N, Hewitt K, Brux M, Hofmann A, Morawietz H, Brunssen C
|
Cigarette smoke extract counteracts atheroprotective effects of high laminar flow on endothelial function.
|
Redox Biol. 2017 Aug;12:776-786
|
|
Cell Biology
|
|
28432984 |
Cigarette smoke extract; Endothelial cells; Endothelial dysfunction; Monocyte adhesion; NRF2; Shear stress and laminar flow |
Tobacco smoking and hemodynamic forces are key stimuli in the development of endothelial dysfunction and atherosclerosis. High laminar flow has an atheroprotective effect on the endothelium and leads to a reduced response of endothelial cells to cardiovascular risk factors compared to regions with disturbed or low laminar flow. We hypothesize that the atheroprotective effect of high laminar flow could delay the development of endothelial dysfunction caused by cigarette smoking. Primary human endothelial cells were stimulated with increasing dosages of aqueous cigarette smoke extract (CSEaq). CSEaq reduced cell viability in a dose-dependent manner. The main mediator of cellular adaption to oxidative stress, nuclear factor erythroid 2-related factor 2 (NRF2) and its target genes heme oxygenase (decycling) 1 (HMOX1) or NAD(P)H quinone dehydrogenase 1 (NQO1) were strongly increased by CSEaq in a dose-dependent manner. High laminar flow induced elongation of endothelial cells in the direction of flow, activated the AKT/eNOS pathway, increased eNOS expression, phosphorylation and NO release. These increases were inhibited by CSEaq. Pro-inflammatory adhesion molecules intercellular adhesion molecule-1 (ICAM1), vascular cell adhesion molecule-1 (VCAM1), selectin E (SELE) and chemokine (C-C motif) ligand 2 (CCL2/MCP-1) were increased by CSEaq. Low laminar flow induced VCAM1 and SELE compared to high laminar flow. High laminar flow improved endothelial wound healing. This protective effect was inhibited by CSEaq in a dose-dependent manner through the AKT/eNOS pathway. Low as well as high laminar flow decreased adhesion of monocytes to endothelial cells. Whereas, monocyte adhesion was increased by CSEaq under low laminar flow, this was not evident under high laminar flow. This study shows the activation of major atherosclerotic key parameters by CSEaq. Within this process, high laminar flow is likely to reduce the harmful effects of CSEaq to a certain degree. The identified molecular mechanisms might be useful for development of alternative therapy concepts. |
|
Klotzsche-von Ameln A, Cremer S, Hoffmann J, Schuster P, Khedr S, Korovina I, Troullinaki M, Neuwirth A, Sprott D, Chatzigeorgiou A, Economopoulou M, Orlandi A, Hain A, Zeiher AM, Deussen A, Hajishengallis G, Dimmeler S, Chavakis T, Chavakis E
|
Endogenous developmental endothelial locus-1 limits ischaemia-related angiogenesis by blocking inflammation.
|
Thromb Haemost. 2017 Jun 2;117(6):1150-1163
|
|
Medical Biology
|
|
28447099 |
Angiogenesis; integrins; leukocytes |
We have recently identified endothelial cell-secreted developmental endothelial locus-1 (Del-1) as an endogenous inhibitor of β2-integrin-dependent leukocyte infiltration. Del-1 was previously also implicated in angiogenesis. Here, we addressed the role of endogenously produced Del-1 in ischaemia-related angiogenesis. Intriguingly, Del-1-deficient mice displayed increased neovascularisation in two independent ischaemic models (retinopathy of prematurity and hind-limb ischaemia), as compared to Del-1-proficient mice. On the contrary, angiogenic sprouting in vitro or ex vivo (aortic ring assay) and physiological developmental retina angiogenesis were not affected by Del-1 deficiency. Mechanistically, the enhanced ischaemic neovascularisation in Del-1-deficiency was linked to higher infiltration of the ischaemic tissue by CD45+ haematopoietic and immune cells. Moreover, Del-1-deficiency promoted β2-integrin-dependent adhesion of haematopoietic cells to endothelial cells in vitro, and the homing of hematopoietic progenitor cells and of immune cell populations to ischaemic muscles in vivo. Consistently, the increased hind limb ischaemia-related angiogenesis in Del-1 deficiency was completely reversed in mice lacking both Del-1 and the β2-integrin LFA-1. Additionally, enhanced retinopathy-associated neovascularisation in Del-1-deficient mice was reversed by LFA-1 blockade. Our data reveal a hitherto unrecognised function of endogenous Del-1 as a local inhibitor of ischaemia-induced angiogenesis by restraining LFA-1-dependent homing of pro-angiogenic haematopoietic cells to ischaemic tissues. Our findings are relevant for the optimisation of therapeutic approaches in the context of ischaemic diseases. |
|
Ocaña-Morgner C, Sales S, Rothe M, Shevchenko A, Jessberger R
|
Tolerogenic versus Immunogenic Lipidomic Profiles of CD11c+ Immune Cells and Control of Immunogenic Dendritic Cell Ceramide Dynamics.
|
J Immunol. 2017 Jun 1;198(11):4360-4372
|
|
Medical Biology
|

|
28468968 |
|
Lipids affect the membrane properties determining essential biological processes. Earlier studies have suggested a role of switch-activated protein 70 (SWAP-70) in lipid raft formation of dendritic cells. We used lipidomics combined with genetic and biochemical assays to analyze the role of SWAP-70 in lipid dynamics. TLR activation using LPS as a ligand represented a pathogenic immunogenic stimulus, physical disruption of cell-cell contacts a tolerogenic stimulus. Physical disruption, but not LPS, caused an increase of phosphatidylcholine ether and cholesteryl esters in CD11c+ immune cells. An increase of ceramide (Cer) was a hallmark for LPS activation. SWAP-70 was required for regulating the increase and localization of Cers in the cell membrane. SWAP-70 controls Cer accumulation through the regulation of pH-dependent acid-sphingomyelinase activity and of RhoA-dependent transport of endosomal contents to the plasma membrane. Poor accumulation of Cers in Swap70-/- cells caused decreased apoptosis. This shows that two different pathways of activation, immunogenic and tolerogenic, induce different changes in the lipid composition of cultured CD11c+ cells, and highlights the important role of SWAP-70 in Cer dynamics in dendritic cells. |
|
Tietze S, Schau I, Michen S, Ennen F, Janke A, Schackert G, Aigner A, Appelhans D, Temme A
|
A Poly(Propyleneimine) Dendrimer-Based Polyplex-System for Single-Chain Antibody-Mediated Targeted Delivery and Cellular Uptake of SiRNA.
|
Small. 2017 Jul;13(27)
|
|
Medical Biology
|

|
28544767 |
poly(propyleneimine); polyplexes; siRNA; single chain antibodies; targeted delivery |
Therapeutics based on small interfering RNAs (siRNAs) offer a great potential to treat so far incurable diseases or metastatic cancer. However, the broad application of siRNAs using various nonviral carrier systems is hampered by unspecific toxic side effects, poor pharmacokinetics due to unwanted delivery of siRNA-loaded nanoparticles into nontarget organs, or rapid renal excretion. In order to overcome these obstacles, several targeting strategies using chemically linked antibodies and ligands have emerged. This study reports a new modular polyplex carrier system for targeted delivery of siRNA, which is based on transfection-disabled maltose-modified poly(propyleneimine)-dendrimers (mal-PPI) bioconjugated to single chain fragment variables (scFvs). To achieve targeted delivery into tumor cells expressing the epidermal growth factor receptor variant III (EGFRvIII), monobiotinylated anti-EGFRvIII scFv fused to a Propionibacterium shermanii transcarboxylase-derived biotinylation acceptor (P-BAP) is bioconjugated to mal-PPI through a novel coupling strategy solely based on biotin-neutravidin bridging. In contrast to polyplexes containing an unspecific control scFv-P-BAP, the generated EGFRvIII-specific polyplexes are able to exclusively deliver siRNA to tumor cells and tumors by receptor-mediated endocytosis. These results suggest that receptor-mediated uptake of otherwise noninternalized mal-PPI-based polyplexes is a promising avenue to improve siRNA therapy of cancer, and introduce a novel strategy for modular bioconjugation of protein ligands to nanoparticles. |
|
Kräter M, Jacobi A, Otto O, Tietze S, Müller K, Poitz DM, Palm S, Zinna VM, Biehain U, Wobus M, Chavakis T, Werner C, Guck J, Bornhauser M
|
Bone marrow niche-mimetics modulate HSPC function via integrin signaling.
|
Sci Rep. 2017 May 31;7(1):2549
|
|
Cell Biology
|

|
28566689 |
|
The bone marrow (BM) microenvironment provides critical physical cues for hematopoietic stem and progenitor cell (HSPC) maintenance and fate decision mediated by cell-matrix interactions. However, the mechanisms underlying matrix communication and signal transduction are less well understood. Contrary, stem cell culture is mainly facilitated in suspension cultures. Here, we used bone marrow-mimetic decellularized extracellular matrix (ECM) scaffolds derived from mesenchymal stromal cells (MSCs) to study HSPC-ECM interaction. Seeding freshly isolated HSPCs adherent (AT) and non-adherent (SN) cells were found. We detected enhanced expansion and active migration of AT-cells mediated by ECM incorporated stromal derived factor one. Probing cell mechanics, AT-cells displayed naïve cell deformation compared to SN-cells indicating physical recognition of ECM material properties by focal adhesion. Integrin αIIb (CD41), αV (CD51) and β3 (CD61) were found to be induced. Signaling focal contacts via ITGβ3 were identified to facilitate cell adhesion, migration and mediate ECM-physical cues to modulate HSPC function. |
|
Dittfeld C, Haase M, Feilmeier M, Jannasch A, Büttner P, Plötze K, Waldow T, Tugtekin SM
|
Movat Pentachrom stain reveals unexpected high osteogenesis rate in aortic valves.
|
Acta Histochem. 2017 Jun;119(5):533-537
|
|
Medical Biology
|

|
28579288 |
Calcific aortic valve stenosis; Movat pentachrom stain; Osseous and chondromatous metaplasia |
BACKGROUND AND AIM OF THE STUDY:
Aortic valve (AV) stenosis is the most common valvular heart disease with an incidence of 3% for people ≥ 65years in the industrialized world with indication for a surgical or transcatheter valve replacement. Researchers suppose osteogenic processes as key mechanisms in calcific aortic valve stenosis. Recently, Torre et al. published impressive histological analyses and detected osseous and/or chondromatous metaplasia in 15.6% of 6685 native calcified aortic valves. Therefore one HE section per valve originated from the area with the greatest extent of calcification was analyzed. Aim of our experimental setup was to identify regions of neo-osteogenesis and to determine the rate of specimens with active mineralization in human aortic valve tissue by Movat Pentachrom staining of sections of lager tissue segments.
METHODS:
Operational replaced aortic valves of 35 patients, 15 female and 20 male with an average age of 66.2 years were formalin fixed and decalcified using Osteosoft®-solution. Tissue samples were cut and 2μm specimens were stained with Movat Pentachrom to visualize osteogenic regions. Instead of screening a large number of sections, tissue samples were cut up to five times with at least 100μm space each if no region of osseous and/or chondromatous metaplasia was visible.
RESULTS/CONCLUSIONS:
Using this setup, a region of osseous metaplasia was detected in 25 (71.4%) of 35 samples analyzed. In some cases, these regions were small sized and only visible due to the bright color of Movat Pentachrom stain. This leads to the suggestion that a higher rate of calcified aortic valve samples would be classified as cusps with areas of neo-osteogenesis after staining with Movat Pentachrom stain and by the systematic analysis of larger parts of the tissue blocks. |
|
Hickmann L, Steglich A, Gerlach M, Al-Mekhlafi M, Sradnick J, Lachmann P, Sequeira-Lopez MLS, Gomez RA, Hohenstein B, Hugo C, Todorov VT
|
Persistent and inducible neogenesis repopulates progenitor renin lineage cells in the kidney.
|
Kidney Int. 2017 Dec;92(6):1419-1432
|
|
Cell Biology
|

|
28688581 |
renal cell biology; renal development; renal injury; renin-angiotensin system; transgenic mouse |
Renin lineage cells (RLCs) serve as a progenitor cell reservoir during nephrogenesis and after renal injury. The maintenance mechanisms of the RLC pool are still poorly understood. Since RLCs were also identified as a progenitor cell population in bone marrow we first considered that these may be their source in the kidney. However, transplantation experiments in adult mice demonstrated that bone marrow-derived cells do not give rise to RLCs in the kidney indicating their non-hematopoietic origin. Therefore we tested whether RLCs develop in the kidney through neogenesis (de novo differentiation) from cells that have never expressed renin before. We used a murine model to track neogenesis of RLCs by flow cytometry, histochemistry, and intravital kidney imaging. During nephrogenesis RLCs first appear at e14, form a distinct population at e16, and expand to reach a steady state level of 8-10% of all kidney cells in adulthood. De novo differentiated RLCs persist as a clearly detectable population through embryogenesis until at least eight months after birth. Pharmacologic stimulation of renin production with enalapril or glomerular injury induced the rate of RLC neogenesis in the adult mouse kidney by 14% or more than three-fold, respectively. Thus, the renal RLC niche is constantly filled by local de novo differentiation. This process could be stimulated consequently representing a new potential target to beneficially influence repair and regeneration after kidney injury. |
|
Ahlfeld T, Cidonio G, Kilian D, Duin S, Akkineni AR, Dawson JI, Yang S, Lode A, Oreffo ROC, Gelinsky M
|
Development of a clay based bioink for 3D cell printing for skeletal application.
|
Biofabrication. 2017 Jul 25;9(3):034103
|
|
Biomaterials
|

|
28691691 |
|
Three-dimensional printing of cell-laden hydrogels has evolved as a promising approach on the route to patient-specific or complex tissue-engineered constructs. However, it is still challenging to print structures with both, high shape fidelity and cell vitality. Herein, we used a synthetic nanosilicate clay, called Laponite, to build up scaffolds utilising the extrusion-based method 3D plotting. By blending with alginate and methylcellulose, a bioink was developed which allowed easy extrusion, achieving scaffolds with high printing fidelity. Following extrusion, approximately 70%-75% of printed immortalised human mesenchymal stem cells survived and cell viability was maintained over 21 days within the plotted constructs. Mechanical properties of scaffolds comprised of the composite bioink decreased over time when stored under cell culture conditions. Nevertheless, shape of the plotted constructs was preserved even over longer cultivation periods. Laponite is known for its favourable drug delivery properties. Two model proteins, bovine serum albumin and vascular endothelial growth factor were loaded into the bioink. We demonstrate that the release of both growth factors significantly changed to a more sustained profile by inclusion of Laponite in comparison to an alginate-methylcellulose blend in the absence of Laponite. In summary, addition of a synthetic clay, Laponite, improved printability, increased shape fidelity and was beneficial for controlled release of biologically active agents such as growth factors. |
|
Bernhardt A, Schamel M, Gbureck U, Gelinsky M
|
Osteoclastic differentiation and resorption is modulated by bioactive metal ions Co2+, Cu2+ and Cr3+ incorporated into calcium phosphate bone cements.
|
PLoS One. 2017 Aug 1;12(8):e0182109
|
|
Cell Biology
|

|
28763481 |
|
Biologically active metal ions in low doses have the potential to accelerate bone defect healing. For successful remodelling the interaction of bone graft materials with both bone-forming osteoblasts and bone resorbing osteoclasts is crucial. In the present study brushite forming calcium phosphate cements (CPC) were doped with Co2+, Cu2+ and Cr3+ and the influence of these materials on osteoclast differentiation and activity was examined. Human osteoclasts were differentiated from human peripheral blood mononuclear cells (PBMC) both on the surface and in indirect contact to the materials on dentin discs. Release of calcium, phosphate and bioactive metal ions was determined using ICP-MS both in the presence and absence of the cells. While Co2+ and Cu2+ showed a burst release, Cr3+ was released steadily at very low concentrations (below 1 μM) and both calcium and phosphate release of the cements was considerably changed in the Cr3+ modified samples. Direct cultivation of PBMC/osteoclasts on Co2+ cements showed lower attached cell number compared to the reference but high activity of osteoclast specific enzymes tartrate resistant acid phosphatase (TRAP), carbonic anhydrase II (CAII) and cathepsin K (CTSK) and significantly increased gene expression of vitronectin receptor. Indirect cultivation with diluted Co2+ cement extracts revealed highest resorbed area compared to all other modifications and the reference. Cu2+ cements had cytotoxic effect on PBMC/osteoclasts during direct cultivation, while indirect cultivation with diluted extracts from Cu2+ cements did not provoke cytotoxic effects but a strictly inhibited resorption. Cr3+ doped cements did not show cytotoxic effects at all. Gene expression and enzyme activity of CTSK was significantly increased in direct culture. Indirect cultivation with Cr3+ doped cements revealed significantly higher resorbed area compared to the reference. In conclusion Cr3+ doped calcium phosphate cements are an innovative cement modification because of their high cytocompatibility and support of active resorption by osteoclasts. |
|
Subramanian P, Prucnal M, Gercken B, Economopoulou M, Hajishengallis G, Chavakis T.
|
Endothelial cell-specific overexpression of developmental endothelial locus-1 does not influence atherosclerosis development in ApoE-/- mice.
|
Thromb Haemost. 2017 Oct 5;117(10):2003-2005
|
|
Medical Biology
|
|
28796274 |
|
Abstract not available. |
|
Seidel J, Ahlfeld T, Adolph M, Kümmritz S, Steingroewer J, Krujatz F, Bley T, Gelinsky M, Lode A
|
Green bioprinting: extrusion-based fabrication of plant cell-laden biopolymer hydrogel scaffolds.
|
Biofabrication. 2017 Nov 14;9(4):045011
|
|
Biomaterials
|

|
28837040 |
|
Plant cell cultures produce active agents for pharmaceuticals, food and cosmetics. However, up to now process control for plant cell suspension cultures is challenging. A positive impact of cell immobilization, such as encapsulation in hydrogel beads, on secondary metabolites production has been reported for several plant species. The aim of this work was to develop a method for bioprinting of plant cells in order to allow fabrication of free-formed three-dimensional matrices with defined internal pore architecture for in depth characterization of immobilization conditions, cell agglomeration and interactions. By using extrusion-based 3D plotting of a basil cell-laden hydrogel blend consisting of alginate, agarose and methylcellulose (alg/aga/mc), we could demonstrate that bioprinting is applicable to plant cells. The majority of the cells survived plotting and crosslinking and the embedded cells showed high viability and metabolic activity during the investigated cultivation period of 20 d. Beside its compatibility with the plant cells, the novel alg/aga/mc blend allowed fabrication of defined 3D constructs with open macropores both in vertical and horizontal direction which were stable under culture conditions for several weeks. Thus, Green Bioprinting, an additive manufacturing technology processing live cells from the plant kingdom, is a promising new immobilization tool for plant cells that enables the development of new bioprocesses for secondary metabolites production as well as monitoring methods. |
|
Mitroulis I, Chen LS, Singh RP, Kourtzelis I, Economopoulou M, Kajikawa T, Troullinaki M, Ziogas A, Ruppova K, Hosur K, Maekawa T, Wang B, Subramanian P, Tonn T, Verginis P, von Bonin M, Wobus M, Bornhäuser M, Grinenko T, Di Scala M, Hidalgo A, Wielockx B, Hajishengallis G, Chavakis T
|
Secreted protein Del-1 regulates myelopoiesis in the hematopoietic stem cell niche.
|
Clin Invest. 2017 Oct 2;127(10):3624-3639.
|
|
Cell Biology
|

|
28846069 |
|
Hematopoietic stem cells (HSCs) remain mostly quiescent under steady-state conditions but switch to a proliferative state following hematopoietic stress, e.g., bone marrow (BM) injury, transplantation, or systemic infection and inflammation. The homeostatic balance between quiescence, self-renewal, and differentiation of HSCs is strongly dependent on their interactions with cells that constitute a specialized microanatomical environment in the BM known as the HSC niche. Here, we identified the secreted extracellular matrix protein Del-1 as a component and regulator of the HSC niche. Specifically, we found that Del-1 was expressed by several cellular components of the HSC niche, including arteriolar endothelial cells, CXCL12-abundant reticular (CAR) cells, and cells of the osteoblastic lineage. Del-1 promoted critical functions of the HSC niche, as it regulated long-term HSC (LT-HSC) proliferation and differentiation toward the myeloid lineage. Del-1 deficiency in mice resulted in reduced LT-HSC proliferation and infringed preferentially upon myelopoiesis under both steady-state and stressful conditions, such as hematopoietic cell transplantation and G-CSF- or inflammation-induced stress myelopoiesis. Del-1-induced HSC proliferation and myeloid lineage commitment were mediated by β3 integrin on hematopoietic progenitors. This hitherto unknown Del-1 function in the HSC niche represents a juxtacrine homeostatic adaptation of the hematopoietic system in stress myelopoiesis. |
|
Teske C, Schweitzer C, Palamidessi A, Aust DE, Scita G, Weitz J, Welsch T
|
Modulation of RAB5A early endosome trafficking in response to KRas mediated macropinocytic fluxes in pancreatic cancer cells.
|
Biochem Biophys Res Commun. 2017 Nov 4;493(1):528-533
|
|
Cell Biology
|

|
28867190 |
Degradation; Endosome; KRas; Pancreatic cancer; Rab5 |
KRAS is the key mutated gene in pancreatic ductal adenocarcinoma (PDAC). Emerging evidence indicates that KRas modulates endocytic uptake. The present study aimed to explore the fate of early endosomal trafficking under the control of KRas expression in PDAC. Surprisingly, PANC-1 cells lacking KRas exhibited significantly enlarged early and late endosomes containing internalized dextran and epidermal growth factor. Endosome enlargement was accompanied by reduced endosomal degradation. Both KRas silencing and lysosomal blockade caused an upregulation of the master regulator of early endosome biogenesis, RAB5A, which is likely responsible for the expansion of the early endosomal compartment, because simultaneous KRAS/RAB5A knockdown abolished endosome enlargement. In contrast, early endosome shrinkage was seen in MIA PaCa-2 cells despite RAB5A upregulation, indicating that distinct KRas-modulated responses operate in different metabolic subtypes of PDAC. In conclusion, mutant KRAS promotes endosomal degradation in PDAC cell lines, which is impaired by KRAS silencing. Moreover, KRAS silencing activates RAB5A upregulation and drives PDAC subtype-dependent modulation of endosome trafficking |
|
Nowak M, Freudenberg U, Tsurkan MV, Werner C, Levental KR
|
Modular GAG-matrices to promote mammary epithelial morphogenesis in vitro.
|
Biomaterials. 2017 Jan;112:20-30
|
|
Biomaterials
|

|
27741500 |
Biomimetic material; Cell-material interaction; Heparin; Mammary epithelium; Organoid morphogenesis |
Matrix systems used to study complex three-dimensional (3D) cellular processes like mammary epithelial tissue morphogenesis and tumorigenesis ex vivo often require ill-defined biological components, which lead to poor reproducibility and a lack of control over physical parameters. In this study, a well-defined, tunable synthetic biohybrid hydrogel composed of the glycosaminoglycan heparin, star-shaped poly(ethylene glycol) (starPEG), and matrix metalloproteinase- (MMP-) cleavable crosslinkers was applied to dissect the biophysical and biochemical signals promoting human mammary epithelial cell (MEC) morphogenesis. We show that compliant starPEG-heparin matrices promote the development of polarized MEC acini. Both the presence of heparin and MMP-cleavable crosslinks are essential in facilitating MEC morphogenesis without supplementation of exogenous adhesion ligands. In this system, MECs secrete and organize laminin in basement membrane-like assemblies to promote integrin signaling and drive acinar development. Therefore, starPEG-heparin hydrogels provide a versatile platform to study mammary epithelial tissue morphogenesis in a chemically defined and precisely tunable 3D in vitro microenvironment. The system allows investigation of biophysical and biochemical aspects of mammary gland biology and potentially a variety of other organoid culture studies. |
|
Franzmann TM, Jahnel M, Pozniakovsky A, Mahamid J, Holehouse AS, Nüske E, Richter D, Baumeister W, Grill SW, Pappu RV, Hyman AA, Alberti S
|
Phase separation of a yeast prion protein promotes cellular fitness.
|
Science. 2018 Jan 5;359(6371)
|
|
Cell Biology
|

|
29301985 |
|
Despite the important role of prion domains in neurodegenerative disease, their physiological function has remained enigmatic. Previous work with yeast prions has defined prion domains as sequences that form self-propagating aggregates. Here, we uncovered an unexpected function of the canonical yeast prion protein Sup35. In stressed conditions, Sup35 formed protective gels via pH-regulated liquid-like phase separation followed by gelation. Phase separation was mediated by the N-terminal prion domain and regulated by the adjacent pH sensor domain. Phase separation promoted yeast cell survival by rescuing the essential Sup35 translation factor from stress-induced damage. Thus, prion-like domains represent conserved environmental stress sensors that facilitate rapid adaptation in unstable environments by modifying protein phase behavior. |
|
Marrone L, Poser I, Casci I, Japtok J, Reinhardt P, Janosch A, Andree C, Lee HO, Moebius C, Koerner E, Reinhardt L, Cicardi ME, Hackmann K, Klink B, Poletti A, Alberti S, Bickle M, Hermann A, Pandey UB, Hyman AA, Sterneckert JL
|
Isogenic FUS-eGFP iPSC Reporter Lines Enable Quantification of FUS Stress Granule Pathology that Is Rescued by Drugs Inducing Autophagy.
|
Stem Cell Reports. 2018 Feb 13;10(2):375-389
|
|
Cell Biology
|

|
29358088 |
CRISPR/Cas9n; FUS; amyotrophic lateral sclerosis; autophagy; gene editing; induced pluripotent stem cells; stress granules |
Perturbations in stress granule (SG) dynamics may be at the core of amyotrophic lateral sclerosis (ALS). Since SGs are membraneless compartments, modeling their dynamics in human motor neurons has been challenging, thus hindering the identification of effective therapeutics. Here, we report the generation of isogenic induced pluripotent stem cells carrying wild-type and P525L FUS-eGFP. We demonstrate that FUS-eGFP is recruited into SGs and that P525L profoundly alters their dynamics. With a screening campaign, we demonstrate that PI3K/AKT/mTOR pathway inhibition increases autophagy and ameliorates SG phenotypes linked to P525L FUS by reducing FUS-eGFP recruitment into SGs. Using a Drosophila model of FUS-ALS, we corroborate that induction of autophagy significantly increases survival. Finally, by screening clinically approved drugs for their ability to ameliorate FUS SG phenotypes, we identify a number of brain-penetrant anti-depressants and anti-psychotics that also induce autophagy. These drugs could be repurposed as potential ALS treatments. |
|
Mittasch M, Gross P, Nestler M, Fritsch AW, Iserman C, Kar M, Munder M, Voigt A, Alberti S, Grill SW, Kreysing M
|
Non-invasive perturbations of intracellular flow reveal physical principles of cell organization.
|
Nat Cell Biol. 2018 Mar;20(3):344-351
|
|
Imaging Technologies Development
|

|
29403036 |
|
Recent advances in cell biology enable precise molecular perturbations. The spatiotemporal organization of cells and organisms, however, also depends on physical processes such as diffusion or cytoplasmic flows, and strategies to perturb physical transport inside cells are not yet available. Here, we demonstrate focused-light-induced cytoplasmic streaming (FLUCS). FLUCS is local, directional, dynamic, probe-free, physiological, and is even applicable through rigid egg shells or cell walls. We explain FLUCS via time-dependent modelling of thermoviscous flows. Using FLUCS, we demonstrate that cytoplasmic flows drive partitioning-defective protein (PAR) polarization in Caenorhabditis elegans zygotes, and that cortical flows are sufficient to transport PAR domains and invert PAR polarity. In addition, we find that asymmetric cell division is a binary decision based on gradually varying PAR polarization states. Furthermore, the use of FLUCS for active microrheology revealed a metabolically induced fluid-to-solid transition of the yeast cytoplasm. Our findings establish how a wide range of transport-dependent models of cellular organization become testable by FLUCS. |
|
Maharana S, Wang J, Papadopoulos DK, Richter D, Pozniakovsky A, Poser I, Bickle M, Rizk S, Guillén-Boixet J, Franzmann TM, Jahnel M, Marrone L, Chang YT, Sterneckert J, Tomancak P, Hyman AA, Alberti S
|
RNA buffers the phase separation behavior of prion-like RNA binding proteins.
|
Science. 2018 May 25;360(6391):918-921
|
|
Cell Biology
|

|
29650702 |
|
Prion-like RNA binding proteins (RBPs) such as TDP43 and FUS are largely soluble in the nucleus but form solid pathological aggregates when mislocalized to the cytoplasm. What keeps these proteins soluble in the nucleus and promotes aggregation in the cytoplasm is still unknown. We report here that RNA critically regulates the phase behavior of prion-like RBPs. Low RNA/protein ratios promote phase separation into liquid droplets, whereas high ratios prevent droplet formation in vitro. Reduction of nuclear RNA levels or genetic ablation of RNA binding causes excessive phase separation and the formation of cytotoxic solid-like assemblies in cells. We propose that the nucleus is a buffered system in which high RNA concentrations keep RBPs soluble. Changes in RNA levels or RNA binding abilities of RBPs cause aberrant phase transitions. |
|
Kroschwald S, Munder MC, Maharana S, Franzmann TM, Richter D, Ruer M, Hyman AA, Alberti S
|
Different Material States of Pub1 Condensates Define Distinct Modes of Stress Adaptation and Recovery.
|
Cell Rep. 2018 Jun 12;23(11):3327-3339
|
|
Cell Biology
|

|
29898402 |
Hsp104; condensate; cytosolic pH; molecular chaperone; phase separation; phase transition; protein aggregation; stress granule; stress response |
How cells adapt to varying environmental conditions is largely unknown. Here, we show that, in budding yeast, the RNA-binding and stress granule protein Pub1 has an intrinsic property to form condensates upon starvation or heat stress and that condensate formation is associated with cell-cycle arrest. Release from arrest coincides with condensate dissolution, which takes minutes (starvation) or hours (heat shock). In vitro reconstitution reveals that the different dissolution rates of starvation- and heat-induced condensates are due to their different material properties: starvation-induced Pub1 condensates form by liquid-liquid demixing and subsequently convert into reversible gel-like particles; heat-induced condensates are more solid-like and require chaperones for disaggregation. Our data suggest that different physiological stresses, as well as stress durations and intensities, induce condensates with distinct physical properties and thereby define different modes of stress adaptation and rates of recovery. |
|
Decker F, Oriola D, Dalton B, Brugués J
|
Autocatalytic microtubule nucleation determines the size and mass of Xenopus laevis egg extract spindles.
|
Elife. 2018 Jan 11;7
|
|
Biophysics
|

|
29323637 |
autocatalytic process; biophysics; cell biology; cytoskeleton; laser ablation; microtubule nucleation; organelle size; spindle; structural biology; xenopus |
Regulation of size and growth is a fundamental problem in biology. A prominent example is the formation of the mitotic spindle, where protein concentration gradients around chromosomes are thought to regulate spindle growth by controlling microtubule nucleation. Previous evidence suggests that microtubules nucleate throughout the spindle structure. However, the mechanisms underlying microtubule nucleation and its spatial regulation are still unclear. Here, we developed an assay based on laser ablation to directly probe microtubule nucleation events in Xenopus laevis egg extracts. Combining this method with theory and quantitative microscopy, we show that the size of a spindle is controlled by autocatalytic growth of microtubules, driven by microtubule-stimulated microtubule nucleation. The autocatalytic activity of this nucleation system is spatially regulated by the limiting amounts of active microtubule nucleators, which decrease with distance from the chromosomes. This mechanism provides an upper limit to spindle size even when resources are not limiting. |
|
Grohme MA, Schloissnig S, Rozanski A, Pippel M, Young GR, Winkler S, Brandl H, Henry I, Dahl A, Powell S, Hiller M, Myers E, Rink JC
|
The genome of Schmidtea mediterranea and the evolution of core cellular mechanisms.
|
Nature. 2018 Feb 1;554(7690):56-61
|
|
Cell Biology
|

|
29364871 |
|
The planarian Schmidtea mediterranea is an important model for stem cell research and regeneration, but adequate genome resources for this species have been lacking. Here we report a highly contiguous genome assembly of S. mediterranea, using long-read sequencing and a de novo assembler (MARVEL) enhanced for low-complexity reads. The S. mediterranea genome is highly polymorphic and repetitive, and harbours a novel class of giant retroelements. Furthermore, the genome assembly lacks a number of highly conserved genes, including critical components of the mitotic spindle assembly checkpoint, but planarians maintain checkpoint function. Our genome assembly provides a key model system resource that will be useful for studying regeneration and the evolutionary plasticity of core cell biological mechanisms. |
|
Florio M, Heide M, Pinson A, Brandl H, Albert M, Winkler S, Wimberger P, Huttner WB, Hiller M
|
Evolution and cell-type specificity of human-specific genes preferentially expressed in progenitors of fetal neocortex.
|
Elife. 2018 Mar 21;7
|
|
Neurobiology
|

|
29561261 |
developmental biology; gene evolution; human; human-specific genes; mouse; neocortex development; neocortex evolution; neural stem cells; neuroscience; primate-specific genes; stem cells |
Understanding the molecular basis that underlies the expansion of the neocortex during primate, and notably human, evolution requires the identification of genes that are particularly active in the neural stem and progenitor cells of the developing neocortex. Here, we have used existing transcriptome datasets to carry out a comprehensive screen for protein-coding genes preferentially expressed in progenitors of fetal human neocortex. We show that 15 human-specific genes exhibit such expression, and many of them evolved distinct neural progenitor cell-type expression profiles and levels compared to their ancestral paralogs. Functional studies on one such gene, NOTCH2NL, demonstrate its ability to promote basal progenitor proliferation in mice. An additional 35 human genes with progenitor-enriched expression are shown to have orthologs only in primates. Our study provides a resource of genes that are promising candidates to exert specific, and novel, roles in neocortical development during primate, and notably human, evolution. |
|
Vaid S, Camp JG, Hersemann L, Eugster Oegema C, Heninger AK, Winkler S, Brandl H, Sarov M, Treutlein B, Huttner WB, Namba T
|
A novel population of Hopx-dependent basal radial glial cells in the developing mouse neocortex.
|
Development. 2018 Oct 18;145(20)
|
|
Developmental Biology
|

|
30266827 |
Basal radial glial cell; Development; Evolution; Hopx; Neocortex |
A specific subpopulation of neural progenitor cells, the basal radial glial cells (bRGCs) of the outer subventricular zone (OSVZ), are thought to have a key role in the evolutionary expansion of the mammalian neocortex. In the developing lissencephalic mouse neocortex, bRGCs exist at low abundance and show significant molecular differences from bRGCs in developing gyrencephalic species. Here, we demonstrate that the developing mouse medial neocortex (medNcx), in contrast to the canonically studied lateral neocortex (latNcx), exhibits an OSVZ and an abundance of bRGCs similar to that in developing gyrencephalic neocortex. Unlike bRGCs in developing mouse latNcx, the bRGCs in medNcx exhibit human bRGC-like gene expression, including expression of Hopx, a human bRGC marker. Disruption of Hopx expression in mouse embryonic medNcx and forced Hopx expression in mouse embryonic latNcx demonstrate that Hopx is required and sufficient, respectively, for bRGC abundance as found in the developing gyrencephalic neocortex. Taken together, our data identify a novel bRGC subpopulation in developing mouse medNcx that is highly related to bRGCs of developing gyrencephalic neocortex. |
|
Enos SJ, Dressler M, Gomes BF, Hyman AA, Woodruff JB
|
Phosphatase PP2A and microtubule-mediated pulling forces disassemble centrosomes during mitotic exit.
|
Biol Open. 2018 Jan 12;7(1)
|
|
Cell Biology
|

|
29222174 |
Centrosome; Disassembly; LET-92; Pericentriolar material; Phosphatase PP2A; SPD-5 |
Centrosomes are microtubule-nucleating organelles that facilitate chromosome segregation and cell division in metazoans. Centrosomes comprise centrioles that organize a micron-scale mass of protein called pericentriolar material (PCM) from which microtubules nucleate. During each cell cycle, PCM accumulates around centrioles through phosphorylation-mediated assembly of PCM scaffold proteins. During mitotic exit, PCM swiftly disassembles by an unknown mechanism. Here, we used Caenorhabditis elegans embryos to determine the mechanism and importance of PCM disassembly in dividing cells. We found that the phosphatase PP2A and its regulatory subunit SUR-6 (PP2ASUR-6), together with cortically directed microtubule pulling forces, actively disassemble PCM. In embryos depleted of these activities, ∼25% of PCM persisted from one cell cycle into the next. Purified PP2ASUR-6 could dephosphorylate the major PCM scaffold protein SPD-5 in vitro Our data suggest that PCM disassembly occurs through a combination of dephosphorylation of PCM components and force-driven fragmentation of the PCM scaffold. |
|
Naumann M, Pal A, Goswami A, Lojewski X, Japtok J, Vehlow A, Naujock M, Günther R, Jin M, Stanslowsky N, Reinhardt P, Sterneckert J, Frickenhaus M, Pan-Montojo F, Storkebaum E, Poser I, Freischmidt A, Weishaupt JH, Holzmann K, Troost D, Ludolph AC, Boeckers TM, Liebau S, Petri S, Cordes N, Hyman AA, Wegner F, Grill SW, Weis J, Storch A, Hermann A
|
Impaired DNA damage response signaling by FUS-NLS mutations leads to neurodegeneration and FUS aggregate formation.
|
Nat Commun. 2018 Jan 23;9(1):335
|
|
Medical Biology
|

|
29362359 |
|
Amyotrophic lateral sclerosis (ALS) is the most frequent motor neuron disease. Cytoplasmic fused in sarcoma (FUS) aggregates are pathological hallmarks of FUS-ALS. Proper shuttling between the nucleus and cytoplasm is essential for physiological cell function. However, the initial event in the pathophysiology of FUS-ALS remains enigmatic. Using human induced pluripotent stem cell (hiPSCs)-derived motor neurons (MNs), we show that impairment of poly(ADP-ribose) polymerase (PARP)-dependent DNA damage response (DDR) signaling due to mutations in the FUS nuclear localization sequence (NLS) induces additional cytoplasmic FUS mislocalization which in turn results in neurodegeneration and FUS aggregate formation. Our work suggests that a key pathophysiologic event in ALS is upstream of aggregate formation. Targeting DDR signaling could lead to novel therapeutic routes for ameliorating ALS. |
|
Hsu F, Spannl S, Ferguson C, Hyman AA, Parton RG, Zerial M
|
Rab5 and Alsin regulate stress-activated cytoprotective signaling on mitochondria.
|
Elife. 2018 Feb 22;7
|
|
Cell Biology
|

|
29469808 |
cell biology; endocytosis; human; inter-organelle signaling; membrane contact sites; trafficking |
Mitochondrial stress response is essential for cell survival, and damaged mitochondria are a hallmark of neurodegenerative diseases. Thus, it is fundamental to understand how mitochondria relay information within the cell. Here, by investigating mitochondrial-endosomal contact sites we made the surprising observation that the small GTPase Rab5 translocates from early endosomes to mitochondria upon oxidative stress. This process is reversible and accompanied by an increase in Rab5-positive endosomes in contact with mitochondria. Interestingly, activation of Rab5 on mitochondria depends on the Rab5-GEF ALS2/Alsin, encoded by a gene mutated in amyotrophic lateral sclerosis (ALS). Alsin-deficient human-induced pluripotent stem cell-derived spinal motor neurons are defective in relocating Rab5 to mitochondria and display increased susceptibility to oxidative stress. These findings define a novel pathway whereby Alsin catalyzes the assembly of the Rab5 endocytic machinery on mitochondria. Defects in stress-sensing by endosomes could be crucial for mitochondrial quality control during the onset of ALS. |
|
Tsoumpekos G, Nemetschke L, Knust E
|
Drosophila Big bang regulates the apical cytocortex and wing growth through junctional tension.
|
J Cell Biol. 2018 Mar 5;217(3):1033-1045
|
|
Cell Biology
|

|
29326288 |
|
Growth of epithelial tissues is regulated by a plethora of components, including signaling and scaffolding proteins, but also by junctional tension, mediated by the actomyosin cytoskeleton. However, how these players are spatially organized and functionally coordinated is not well understood. Here, we identify the Drosophila melanogaster scaffolding protein Big bang as a novel regulator of growth in epithelial cells of the wing disc by ensuring proper junctional tension. Loss of big bang results in the reduction of the regulatory light chain of nonmuscle myosin, Spaghetti squash. This is associated with an increased apical cell surface, decreased junctional tension, and smaller wings. Strikingly, these phenotypic traits of big bang mutant discs can be rescued by expressing constitutively active Spaghetti squash. Big bang colocalizes with Spaghetti squash in the apical cytocortex and is found in the same protein complex. These results suggest that in epithelial cells of developing wings, the scaffolding protein Big bang controls apical cytocortex organization, which is important for regulating cell shape and tissue growth. |
|
Das S, Knust E
|
A dual role of the extracellular domain of Drosophila Crumbs for morphogenesis of the embryonic neuroectoderm.
|
Biol Open. 2018 Jan 26;7(1)
|
|
Developmental Biology
|

|
29374056 |
Actomyosin; Adhesion; Neurogenesis; Notch; Polarity |
Epithelia are highly polarised tissues and several highly conserved polarity protein complexes serve to establish and maintain polarity. The transmembrane protein Crumbs (Crb), the central component of the Crb protein complex, is required, among others, for the maintenance of polarity in most epithelia in the Drosophila embryo. However, different epithelia exhibit different phenotypic severity upon loss of crb Using a transgenomic approach allowed us to more accurately define the role of crb in different epithelia. In particular, we provide evidence that the loss of epithelial tissue integrity in the ventral epidermis of crb mutant embryos is due to impaired actomyosin activity and an excess number of neuroblasts. We demonstrate that the intracellular domain of Crb could only partially rescue this phenotype, while it is able to completely restore tissue integrity in other epithelia. Based on these results we suggest a dual role of the extracellular domain of Crb in the ventral neuroectoderm. First, it is required for apical enrichment of the Crb protein, which in turn regulates actomyosin activity and thereby ensures tissue integrity; and second, the extracellular domain of Crb stabilises the Notch receptor and thereby ensures proper Notch signalling and specification of the correct number of neuroblasts. |
|
Crespo C, Soroldoni D, Knust E
|
A novel transgenic zebrafish line for red opsin expression in outer segments of photoreceptor cells.
|
Dev Dyn. 2018 Jul;247(7):951-959
|
|
Developmental Biology
|

|
29603474 |
Development; LWS1; LWS2; cone cells; retina |
BACKGROUND:Opsins are a group of light-sensitive proteins present in photoreceptor cells, which convert the energy of photons into electrochemical signals, thus allowing vision. Given their relevance, we aimed to visualize the two red opsins at subcellular scale in photoreceptor cells.
RESULTS:We generated a novel Zebrafish BAC transgenic line, which express fluorescently tagged, full-length Opsin 1 long-wave-sensitive 1 (Opn1lw1) and full-length Opsin 1 long-wave-sensitive 2 (Opn1lw2) under the control of their endogenous promoters. Both fusion proteins are localized in the outer segments of photoreceptor cells. During development, Opn1lw2-mKate2 is detected from the initial formation of outer segments onward. In contrast, Opn1lw1-mNeonGreen is first detected in juvenile Zebrafish at about 2 weeks postfertilization, and both opsins continue to be expressed throughout adulthood. It is important to note that the presence of the transgene did not significantly alter the size of outer segments.
CONCLUSIONS:We have generated a transgenic line that mimics the endogenous expression pattern of Opn1lw1 and Opn1lw2 in the developing and adult retina. In contrast to existing lines, our transgene design allows to follow protein localization. Hence, we expect that these lines could act as useful real-time reporters to directly measure phenomena in retinal development and disease models. |
|
Crespo C, Knust E
|
Characterisation of maturation of photoreceptor cell subtypes during zebrafish retinal development.
|
Biol Open. 2018 Oct 31;7(11)
|
|
Developmental Biology
|

|
30237290 |
Chromatin; Growth; Light; Mitochondria; Nuclei; Polarity |
Photoreceptor cells (PRCs) mature from simple epithelial cells, a process characterised by growth and compartmentalisation of the apical membrane into an inner and an outer segment. So far, a PRC subtype-specific description of morphological and cellular changes in the developing zebrafish retina is missing. Here, we performed an in-depth characterisation of four of the five PRC subtypes of the zebrafish retina between 51 and 120 h post fertilisation, including quantification of the size of different compartments, localisation of polarity proteins and positioning of organelles. One of the major findings was the anisotropic and subtype-specific growth of the different PRC compartments. In addition, a transient accumulation of endoplasmic reticulum in rod PRCs, changes in chromatin organisation in UV sensitive cones and differential expression of polarity proteins during the initial stages of PRC maturation were observed. The results obtained provide a developmental timeline that can be used as a platform for future studies on PRC maturation and function. This platform was applied to document that increased exposure to light leads to smaller apical domains of PRCs. |
|
Weigert M, Subramanian K, Bundschuh ST, Myers EW, Kreysing M
|
Biobeam-Multiplexed wave-optical simulations of light-sheet microscopy.
|
PLoS Comput Biol. 2018 Apr 13;14(4):e1006079
|
|
Image Processing
|

|
29652879 |
|
Sample-induced image-degradation remains an intricate wave-optical problem in light-sheet microscopy. Here we present biobeam, an open-source software package that enables simulation of operational light-sheet microscopes by combining data from 105-106 multiplexed and GPU-accelerated point-spread-function calculations. The wave-optical nature of these simulations leads to the faithful reproduction of spatially varying aberrations, diffraction artifacts, geometric image distortions, adaptive optics, and emergent wave-optical phenomena, and renders image-formation in light-sheet microscopy computationally tractable. |
|
Drobot B, Iglesias-Artola JM, Le Vay K, Mayr V, Kar M, Kreysing M, Mutschler H, Tang TD
|
Compartmentalised RNA catalysis in membrane-free coacervate protocells.
|
Nat Commun. 2018 Sep 7;9(1):3643
|
|
Biophysics
|

|
30194374 |
|
Phase separation of mixtures of oppositely charged polymers provides a simple and direct route to compartmentalisation via complex coacervation, which may have been important for driving primitive reactions as part of the RNA world hypothesis. However, to date, RNA catalysis has not been reconciled with coacervation. Here we demonstrate that RNA catalysis is viable within coacervate microdroplets and further show that these membrane-free droplets can selectively retain longer length RNAs while permitting transfer of lower molecular weight oligonucleotides. |
|
Wagner N, Stephan M, Höglinger D, Nadler A
|
A Click Cage: Organelle-Specific Uncaging of Lipid Messengers.
|
Angew Chem Int Ed Engl. 2018 Oct 1;57(40):13339-13343
|
|
Applied Chemistry
|

|
30048020 |
arachidonic acid; caged compounds; calcium signaling; organelle-specific photorelease; sphingosine |
Lipid messengers exert their function on short time scales at distinct subcellular locations, yet most experimental approaches for perturbing their levels trigger cell-wide concentration changes. Herein, we report on a coumarin-based photocaging group that can be modified with organelle-targeting moieties by click chemistry and thus enables photorelease of lipid messengers in distinct organelles. We show that caged arachidonic acid and sphingosine derivatives can be selectively delivered to mitochondria, the ER, lysosomes, and the plasma membrane. By comparing the cellular calcium transients induced by localized uncaging of arachidonic acid and sphingosine, we show that the precise intracellular localization of the released second messenger is crucial for the signaling outcome. Ultimately, we anticipate that this new class of caged compounds will greatly facilitate the study of cellular processes on the organelle level. |
|
Yanakieva I, Matejčić M, Norden C
|
Choosing the right microscope to image mitosis in zebrafish embryos: A practical guide. Yanakieva I1, Matejčić M2, Norden C3.
|
Methods Cell Biol. 2018;145:107-127
|
|
Developmental Biology
|

|
29957200 |
LSCM; LSFM; Live-imaging; Mitotic index; Neuroepithelia; Phototoxicity; SDCM; Zebrafish |
Tissue growth and organismal development require orchestrated cell proliferation. To understand how cell division guides development, it is important to explore mitosis at the tissue-wide, cellular, and subcellular scale. At the tissue level this includes determining a tissue's mitotic index, at the cellular level the tracing of cell lineages, and at the subcellular level the characterization of intracellular components. These different tasks can be addressed by different imaging approaches (e.g., laser-scanning confocal, spinning disk confocal, and light-sheet fluorescence microscopy). Here, we summarize three protocols for exploring different facets of mitosis in developing zebrafish embryos. Zebrafish embryos are transparent and their rapid external development greatly facilitates the study of cellular processes and developmental dynamics using microscopy. A critical step in all imaging studies of mitosis in development is to choose the most suitable microscope for each scientific question. This choice is important in order to ensure a balance between the required temporal and spatial resolution and minimal phototoxicity that could otherwise perturb the process of interest. The use of different microscopy techniques, best suited for the purpose of each experiment, thus permits to generate a comprehensive and unbiased view on how mitosis influences development. |
|
Matejčić M, Salbreux G, Norden C
|
A non-cell-autonomous actin redistribution enables isotropic retinal growth.
|
PLoS Biol. 2018 Aug 10;16(8)
|
|
Developmental Biology
|

|
30096143 |
|
Tissue shape is often established early in development and needs to be scaled isotropically during growth. However, the cellular contributors and ways by which cells interact tissue-wide to enable coordinated isotropic tissue scaling are not yet understood. Here, we follow cell and tissue shape changes in the zebrafish retinal neuroepithelium, which forms a cup with a smooth surface early in development and maintains this architecture as it grows. By combining 3D analysis and theory, we show how a global increase in cell height can maintain tissue shape during growth. Timely cell height increase occurs concurrently with a non-cell-autonomous actin redistribution. Blocking actin redistribution and cell height increase perturbs isotropic scaling and leads to disturbed, folded tissue shape. Taken together, our data show how global changes in cell shape enable isotropic growth of the developing retinal neuroepithelium, a concept that could also apply to other systems. |
|
Daniel K, Icha J, Horenburg C, Müller D, Norden C, Mansfeld J
|
Conditional control of fluorescent protein degradation by an auxin-dependent nanobody.
|
Nat Commun. 2018 Aug 17;9(1):3297
|
|
Cell Biology
|

|
30120238 |
|
The conditional and reversible depletion of proteins by auxin-mediated degradation is a powerful tool to investigate protein functions in cells and whole organisms. However, its wider applications require fusing the auxin-inducible degron (AID) to individual target proteins. Thus, establishing the auxin system for multiple proteins can be challenging. Another approach for directed protein degradation are anti-GFP nanobodies, which can be applied to GFP stock collections that are readily available in different experimental models. Here, we combine the advantages of auxin and nanobody-based degradation technologies creating an AID-nanobody to degrade GFP-tagged proteins at different cellular structures in a conditional and reversible manner in human cells. We demonstrate efficient and reversible inactivation of the anaphase promoting complex/cyclosome (APC/C) and thus provide new means to study the functions of this essential ubiquitin E3 ligase. Further, we establish auxin degradation in a vertebrate model organism by employing AID-nanobodies in zebrafish. |
|
Knittelfelder O, Traikov S, Vvedenskaya O, Schuhmann A, Segeletz S, Shevchenko A, Shevchenko A
|
Shotgun Lipidomics Combined with Laser Capture Microdissection: A Tool To Analyze Histological Zones in Cryosections of Tissues.
|
Anal Chem. 2018 Aug 21;90(16):9868-9878
|
|
Cell Biology
|

|
30004672 |
|
Shotgun analysis provides a quantitative snapshot of the lipidome composition of cells, tissues, or model organisms; however, it does not elucidate the spatial distribution of lipids. Here we demonstrate that shotgun analysis could quantify low-picomole amounts of lipids isolated by laser capture microdissection (LCM) of hundred micrometer-sized histological zones visualized at the cryosections of tissues. We identified metabolically distinct periportal (pp) and pericentral (pc) zones by immunostaining of 20 μm thick cryosections of a healthy mouse liver. LCM was used to ablate, catapult, and collect the tissue material from 10 to 20 individual zones covering a total area of 0.3-0.5 mm2 and containing ca. 500 cells. Top-down shotgun profiling relying upon computational stitching of 61 targeted selective ion monitoring ( t-SIM) spectra quantified more than 200 lipid species from 17 lipid classes including glycero- and glycerophospholipids, sphingolipids, cholesterol esters, and cholesterol. Shotgun LCM revealed the overall commonality of the full lipidome composition of pp and pc zones along with significant ( p < 0.001) difference in the relative abundance of 13 lipid species. Follow-up proteomics analyses of pellets recovered from an aqueous phase saved after the lipid extraction identified 13 known and 7 new protein markers exclusively present in pp or in pc zones and independently validated the specificity of their visualization, isolation, and histological assignment. |
|
Tang TD, Cecchi D, Fracasso G, Accardi D, Coutable-Pennarun A, Mansy SS, Perriman AW, Anderson JLR, Mann S
|
Gene-Mediated Chemical Communication in Synthetic Protocell Communities.
|
ACS Synth Biol. 2018 Feb 16;7(2):339-346
|
|
Cell Biology
|

|
29091420 |
cell-free expression; communication; enzyme cascade; genetic switches; lipid vesicles; proteinosomes; α-hemolysin |
A gene-directed chemical communication pathway between synthetic protocell signaling transmitters (lipid vesicles) and receivers (proteinosomes) was designed, built and tested using a bottom-up modular approach comprising small molecule transcriptional control, cell-free gene expression, porin-directed efflux, substrate signaling, and enzyme cascade-mediated processing. |
|
Solimena M, Schulte AM, Marselli L, Ehehalt F, Richter D, Kleeberg M, Mziaut H, Knoch KP, Parnis J, Bugliani M, Siddiq A, Jörns A, Burdet F, Liechti R, Suleiman M, Margerie D, Syed F, Distler M, Grützmann R15, Petretto E, Moreno-Moral A, Wegbrod C, Sönmez A, Pfriem K, Friedrich A, Meinel J, Wollheim CB, Baretton GB, Scharfmann R, Nogoceke E, Bonifacio E, Sturm D, Meyer-Puttlitz B, Boggi U, Saeger HD, Filipponi F, Lesche M, Meda P, Dahl A, Wigger L, Xenarios I, Falchi M, Thorens B, Weitz J, Bokvist K, Lenzen S, Rutter GA, Froguel P, von Bülow M, Ibberson M, Marchetti P
|
Systems biology of the IMIDIA biobank from organ donors and pancreatectomised patients defines a novel transcriptomic signature of islets from individuals with type 2 diabetes.
|
Diabetologia. 2018 Mar;61(3):641-657
|
|
Medical Biology
|
|
29185012 |
Beta cell; Biobank; Diabetes; Gene expression; Insulin secretion; Islet; Laser capture microdissection; Organ donor; Pancreatectomy; Systems biology |
AIMS/HYPOTHESIS:Pancreatic islet beta cell failure causes type 2 diabetes in humans. To identify transcriptomic changes in type 2 diabetic islets, the Innovative Medicines Initiative for Diabetes: Improving beta-cell function and identification of diagnostic biomarkers for treatment monitoring in Diabetes (IMIDIA) consortium ( www.imidia.org ) established a comprehensive, unique multicentre biobank of human islets and pancreas tissues from organ donors and metabolically phenotyped pancreatectomised patients (PPP).
METHODS:Affymetrix microarrays were used to assess the islet transcriptome of islets isolated either by enzymatic digestion from 103 organ donors (OD), including 84 non-diabetic and 19 type 2 diabetic individuals, or by laser capture microdissection (LCM) from surgical specimens of 103 PPP, including 32 non-diabetic, 36 with type 2 diabetes, 15 with impaired glucose tolerance (IGT) and 20 with recent-onset diabetes (<1 year), conceivably secondary to the pancreatic disorder leading to surgery (type 3c diabetes). Bioinformatics tools were used to (1) compare the islet transcriptome of type 2 diabetic vs non-diabetic OD and PPP as well as vs IGT and type 3c diabetes within the PPP group; and (2) identify transcription factors driving gene co-expression modules correlated with insulin secretion ex vivo and glucose tolerance in vivo. Selected genes of interest were validated for their expression and function in beta cells.
RESULTS:Comparative transcriptomic analysis identified 19 genes differentially expressed (false discovery rate ≤0.05, fold change ≥1.5) in type 2 diabetic vs non-diabetic islets from OD and PPP. Nine out of these 19 dysregulated genes were not previously reported to be dysregulated in type 2 diabetic islets. Signature genes included TMEM37, which inhibited Ca2+-influx and insulin secretion in beta cells, and ARG2 and PPP1R1A, which promoted insulin secretion. Systems biology approaches identified HNF1A, PDX1 and REST as drivers of gene co-expression modules correlated with impaired insulin secretion or glucose tolerance, and 14 out of 19 differentially expressed type 2 diabetic islet signature genes were enriched in these modules. None of these signature genes was significantly dysregulated in islets of PPP with impaired glucose tolerance or type 3c diabetes.
CONCLUSIONS/INTERPRETATION:These studies enabled the stringent definition of a novel transcriptomic signature of type 2 diabetic islets, regardless of islet source and isolation procedure. Lack of this signature in islets from PPP with IGT or type 3c diabetes indicates differences possibly due to peculiarities of these hyperglycaemic conditions and/or a role for duration and severity of hyperglycaemia. Alternatively, these transcriptomic changes capture, but may not precede, beta cell failure. |
|
Kesavan G, Hammer J, Hans S, Brand M
|
Targeted knock-in of CreER T2 in zebrafish using CRISPR/Cas9.
|
Cell Tissue Res. 2018 Apr;372(1):41-50
|
|
Cell Biology
|

|
29435650 |
CRISPR/Cas9; Cre-loxp recombination; CreER T2; Knock-in; Zebrafish |
New genome-editing approaches, such as the CRISPR/Cas system, have opened up great opportunities to insert or delete genes at targeted loci and have revolutionized genetics in model organisms like the zebrafish. The Cre-loxp recombination system is widely used to activate or inactivate genes with high spatial and temporal specificity. Using a CRISPR/Cas9-mediated knock-in strategy, we inserted a zebrafish codon-optimized CreER T2 transgene at the otx2 gene locus to generate a conditional Cre-driver line. We chose otx2 as it is a patterning gene of the anterior neural plate that is expressed during early development. By knocking in CreER T2 upstream of the endogenous ATG of otx2, we utilized this gene's native promoter and enhancer elements to perfectly match CreER T2 and endogenous otx2 expression patterns. Next, by combining this novel driver line with a Cre-dependent reporter line, we show that only in the presence of tamoxifen can efficient Cre-loxp-mediated recombination be achieved in the anterior neural plate-derived tissues like the telencephalon, the eye and the optic tectum. Our results imply that the otx2:CreER T2 transgenic fish will be a valuable tool for lineage tracing and conditional mutant studies in larval and adult zebrafish. |
|
Kutsche LK, Gysi DM, Fallmann J, Lenk K, Petri R, Swiersy A, Klapper SD, Pircs K, Khattak S, Stadler PF, Jakobsson J, Nowick K, Busskamp V
|
Combined Experimental and System-Level Analyses Reveal the Complex Regulatory Network of miR-124 during Human Neurogenesis.
|
Cell Syst. 2018 Oct 24;7(4):438-452
|
|
Neurobiology
|

|
30292704 |
AGO2-RIP-seq; ZNF787; gene regulatory network analysis; miR-124 targetome; miRNA dynamics; miRNA regulation; miRNA-transcription factor networks; neuronal differentiation from human stem cells; neuronal miRNAs; systems biology |
Non-coding RNAs regulate many biological processes including neurogenesis. The brain-enriched miR-124 has been assigned as a key player of neuronal differentiation via its complex but little understood regulation of thousands of annotated targets. To systematically chart its regulatory functions, we used CRISPR/Cas9 gene editing to disrupt all six miR-124 alleles in human induced pluripotent stem cells. Upon neuronal induction, miR-124-deleted cells underwent neurogenesis and became functional neurons, albeit with altered morphology and neurotransmitter specification. Using RNA-induced-silencing-complex precipitation, we identified 98 high-confidence miR-124 targets, of which some directly led to decreased viability. By performing advanced transcription-factor-network analysis, we identified indirect miR-124 effects on apoptosis, neuronal subtype differentiation, and the regulation of previously uncharacterized zinc finger transcription factors. Our data emphasize the need for combined experimental- and system-level analyses to comprehensively disentangle and reveal miRNA functions, including their involvement in the neurogenesis of diverse neuronal cell types found in the human brain. |
|
Brosch M, Kattler K, Herrmann A, von Schönfels W, Nordström K, Seehofer D, Damm G, Becker T, Zeissig S, Nehring S, Reichel F, Moser V, Thangapandi RV, Stickel F, Baretton G, Röcken C, Muders M, Matz-Soja M, Krawczak M, Gasparoni G, Hartmann H, Dahl A, Schafmayer C, Walter J, Hampe J
|
Epigenomic map of human liver reveals principles of zonated morphogenic and metabolic control.
|
Nat Commun. 2018 Oct 8;9(1):4150
|
|
Medical Biology
|

|
30297808 |
|
A deeper epigenomic understanding of spatial organization of cells in human tissues is an important challenge. Here we report the first combined positional analysis of transcriptomes and methylomes across three micro-dissected zones (pericentral, intermediate and periportal) of human liver. We identify pronounced anti-correlated transcriptional and methylation gradients including a core of 271 genes controlling zonated metabolic and morphogen networks and observe a prominent porto-central gradient of DNA methylation at binding sites of 46 transcription factors. The gradient includes an epigenetic and transcriptional Wnt signature supporting the concept of a pericentral hepatocyte regeneration pathway under steady-state conditions. While donors with non-alcoholic fatty liver disease show consistent gene expression differences corresponding to the severity of the disease across all zones, the relative zonated gene expression and DNA methylation patterns remain unchanged. Overall our data provide a wealth of new positional insights into zonal networks controlled by epigenetic and transcriptional gradients in human liver. |
|
Korovina I, Neuwirth A, Sprott D, Weber S, Sardar Pasha SPB, Gercken B, Breier G, El-Armouche A, Deussen A, Karl MO, Wielockx B, Chavakis T, Klotzsche-von Ameln A
|
Hematopoietic hypoxia-inducible factor 2α deficiency ameliorates pathological retinal neovascularization via modulation of endothelial cell apoptosis.
|
FASEB J. 2019 Feb;33(2):1758-1770
|
|
Medical Biology
|

|
30156910 |
Adam17; FasL; angiogenesis; microglia; retinopathy |
A hallmark of proliferative retinopathies, such as retinopathy of prematurity (ROP), is a pathological neovascularization orchestrated by hypoxia and the resulting hypoxia-inducible factor (HIF)-dependent response. We studied the role of Hif2α in hematopoietic cells for pathological retina neovascularization in the murine model of ROP, the oxygen-induced retinopathy (OIR) model. Hematopoietic-specific deficiency of Hif2α ameliorated pathological neovascularization in the OIR model, which was accompanied by enhanced endothelial cell apoptosis. That latter finding was associated with up-regulation of the apoptosis-inducer FasL in Hif2α-deficient microglia. Consistently, pharmacological inhibition of the FasL reversed the reduced pathological neovascularization from hematopoietic-specific Hif2α deficiency. Our study found that the hematopoietic cell Hif2α contributes to pathological retina angiogenesis. Our findings not only provide novel insights regarding the complex interplay between immune cells and endothelial cells in hypoxia-driven retina neovascularization but also may have therapeutic implications for proliferative retinopathies.-Korovina, I., Neuwirth, A., Sprott, D., Weber, S., Sardar Pasha, S. P. B., Gercken, B., Breier, G., El-Armouche, A., Deussen, A., Karl, M. O., Wielockx, B., Chavakis, T., Klotzsche-von Ameln, A. Hematopoietic hypoxia-inducible factor 2α deficiency ameliorates pathological retinal neovascularization via modulation of endothelial cell apoptosis. |
|
Papadimitriou C, Celikkaya H, Cosacak MI, Mashkaryan V, Bray L, Bhattarai P, Brandt K, Hollak H, Chen X, He S, Antos CL, Lin W, Thomas AK, Dahl A, Kurth T, Friedrichs J, Zhang Y, Freudenberg U, Werner C, Kizil C
|
3D Culture Method for Alzheimer's Disease Modeling Reveals Interleukin-4 Rescues Aβ42-Induced Loss of Human Neural Stem Cell Plasticity.
|
Dev Cell. 2018 Jul 2;46(1):85-101
|
- LMF CMCB
- EMF & Histo CMCB
|
Neurobiology
|

|
29974866 |
3D starPEG-HEP hydrogel; Alzheimer's disease; amyloid-beta42; cortical neurogenesis; human neural stem cell; interleukin-4; kynurenic acid; neuroinflammation; plasticity; primary human astrocyte |
Neural stem cells (NSCs) constitute an endogenous reservoir for neurons that could potentially be harnessed for regenerative therapies in disease contexts such as neurodegeneration. However, in Alzheimer's disease (AD), NSCs lose plasticity and thus possible regenerative capacity. We investigate how NSCs lose their plasticity in AD by using starPEG-heparin-based hydrogels to establish a reductionist 3D cell-instructive neuro-microenvironment that promotes the proliferative and neurogenic ability of primary and induced human NSCs. We find that administration of AD-associated Amyloid-β42 causes classical neuropathology and hampers NSC plasticity by inducing kynurenic acid (KYNA) production. Interleukin-4 restores NSC proliferative and neurogenic ability by suppressing the KYNA-producing enzyme Kynurenine aminotransferase (KAT2), which is upregulated in APP/PS1dE9 mouse model of AD and in postmortem human AD brains. Thus, our culture system enables a reductionist investigation of regulation of human NSC plasticity for the identification of potential therapeutic targets for intervention in AD. |
|
Janjuha S, Pal Singh S, Ninov N
|
Analysis of Beta-cell Function Using Single-cell Resolution Calcium Imaging in Zebrafish Islets.
|
J Vis Exp. 2018 Jul 3;(137)
|
|
Cell Biology
|

|
30035763 |
|
Pancreatic beta-cells respond to increasing blood glucose concentrations by secreting the hormone insulin. The dysfunction of beta-cells leads to hyperglycemia and severe, life-threatening consequences. Understanding how the beta-cells operate under physiological conditions and what genetic and environmental factors might cause their dysfunction could lead to better treatment options for diabetic patients. The ability to measure calcium levels in beta-cells serves as an important indicator of beta-cell function, as the influx of calcium ions triggers insulin release. Here we describe a protocol for monitoring the glucose-stimulated calcium influx in zebrafish beta-cells by using GCaMP6s, a genetically encoded sensor of calcium. The method allows monitoring the intracellular calcium dynamics with single-cell resolution in ex vivo mounted islets. The glucose-responsiveness of beta-cells within the same islet can be captured simultaneously under different glucose concentrations, which suggests the presence of functional heterogeneity among zebrafish beta-cells. Furthermore, the technique provides high temporal and spatial resolution, which reveals the oscillatory nature of the calcium influx upon glucose stimulation. Our approach opens the doors to use the zebrafish as a model to investigate the contribution of genetic and environmental factors to beta-cell function and dysfunction. |
|
Janjuha S, Singh SP, Tsakmaki A, Mousavy Gharavy SN, Murawala P, Konantz J, Birke S, Hodson DJ, Rutter GA, Bewick GA, Ninov N
|
Age-related islet inflammation marks the proliferative decline of pancreatic beta-cells in zebrafish.
|
Elife. 2018 Apr 6;7
|
|
Cell Biology
|

|
29624168 |
Diabetes; Inflammation; NF-kB; beta-cells; cell biology; pancreas; zebrafish |
The pancreatic islet, a cellular community harboring the insulin-producing beta-cells, is known to undergo age-related alterations. However, only a handful of signals associated with aging have been identified. By comparing beta-cells from younger and older zebrafish, here we show that the aging islets exhibit signs of chronic inflammation. These include recruitment of tnfα-expressing macrophages and the activation of NF-kB signaling in beta-cells. Using a transgenic reporter, we show that NF-kB activity is undetectable in juvenile beta-cells, whereas cells from older fish exhibit heterogeneous NF-kB activity. We link this heterogeneity to differences in gene expression and proliferation. Beta-cells with high NF-kB signaling proliferate significantly less compared to their neighbors with low activity. The NF-kB signalinghi cells also exhibit premature upregulation of socs2, an age-related gene that inhibits beta-cell proliferation. Together, our results show that NF-kB activity marks the asynchronous decline in beta-cell proliferation with advancing age. |
|
Glaß H, Pal A, Reinhardt P, Sterneckert J, Wegner F, Storch A, Hermann A
|
Defective mitochondrial and lysosomal trafficking in chorea-acanthocytosis is independent of Src-kinase signaling.
|
Mol Cell Neurosci. 2018 Oct;92:137-148
|
|
Neurobiology
|

|
30081151 |
Chorea-Acanthocytosis (ChAc); Human induced pluripotent stem cells (iPSC); Lysosomes; Medium spiny neurons (MSNs); Microfluidic chambers; Mitochondria; Organelle trafficking; Tracking |
Mutations in the VPS13A gene leading to depletion of chorein protein are causative for Chorea Acanthocytosis (ChAc), a rare devastating disease, which is characterized by neurodegeneration mainly affecting the basal ganglia as well as deformation of erythrocytes. Studies on patient blood samples highlighted a dysregulation of Actin cytoskeleton caused by downregulation of the PI3K pathway and hyper-activation of Lyn-kinase, but to what extent these mechanisms are present and relevant in the affected neurons remains elusive. We studied the effects of the absence of chorein protein on the morphology and trafficking of lysosomal and mitochondrial compartments in ChAc patient-specific induced pluripotent stem cell-derived medium spiny neurons (MSNs). Numbers of both organelle types were reduced in ChAc MSNs. Mitochondrial length was shortened and their membrane potential showed significant hyperpolarization. In contrast to previous studies, showing Lyn kinase dependency of ChAc-associated pathological events in erythrocytes, pharmacological studies demonstrate that the impairment of mitochondria and lysosomes are independent of Lyn kinase activity. These data suggest that impairment in mitochondrial and lysosomal morphologies in MSNs is not mediated by a dysregulation of Lyn kinase and thus the pathological pathways in ChAc might be - at least in part - cell-type specific. |
|
Marrone L, Bus C, Schöndorf D, Fitzgerald JC, Kübler M, Schmid B, Reinhardt P, Reinhardt L, Deleidi M, Levin T, Meixner A, Klink B, Glatza M, Gloeckner CJ, Gasser T, Sterneckert J
|
Generation of iPSCs carrying a common LRRK2 risk allele for in vitro modeling of idiopathic Parkinson's disease.
|
PLoS One. 2018 Mar 7;13(3)
|
|
Medical Biology
|

|
29513666 |
|
Induced pluripotent stem cells (iPSCs) have recapitulated several aspects of Parkinson's disease (PD), but most iPSCs are derived from familial cases, which account for only about 15% of patients. Thus, while the emphasis has justifiably been on using iPSCs to model rare familial cases, models for the most common forms of PD are critically lacking. Here, we report the generation of an iPSC-based model of idiopathic PD (iPD) with or without RS1491923, which is a common risk variant in the LRRK2 locus. Consistent with GWA studies, we found large variability in our datasets. However, iPSC-derived neurons carrying the risk allele emerged for displaying subtle disturbances of cellular degradative systems, in line with familial PD models. We also observed that treatment with the LRRK2 inhibitor CZC-25146 slightly reduced a marker of aSYN pathology in all iPD lines. Future iPSC-based studies may need to be structured similarly to large GWA studies in order to obtain relevant statistical power. However, results from this pilot study suggest that iPSC-based modeling represents an attractive way to investigate idiopathic diseases. |
|
Albert EA, Puretskaia OA, Terekhanova NV, Labudina A, Bökel C
|
Direct control of somatic stem cell proliferation factors by the Drosophila testis stem cell niche.
|
Development. 2018 Sep 3;145(17)
|
|
Cell Biology
|

|
30002131 |
DamID; Drosophila; Stem cell niche; Zfh1; kibra; salvador |
Niches have traditionally been characterised as signalling microenvironments that allow stem cells to maintain their fate. This definition implicitly assumes that the various niche signals are integrated towards a binary fate decision between stemness and differentiation. However, observations in multiple systems have demonstrated that stem cell properties, such as proliferation and self-renewal, can be uncoupled at the level of niche signalling input, which is incompatible with this simplified view. We have studied the role of the transcriptional regulator Zfh1, a shared target of the Hedgehog and Jak/Stat niche signalling pathways, in the somatic stem cells of the Drosophila testis. We found that Zfh1 binds and downregulates salvador and kibra, two tumour suppressor genes of the Hippo/Wts/Yki pathway, thereby restricting Yki activation and proliferation to the Zfh1+ stem cells. These observations provide an unbroken link from niche signal input to an individual aspect of stem cell behaviour that does not, at any step, involve a fate decision. We discuss the relevance of these findings for an overall concept of stemness and niche function. |
|
Schmidt K, Zhang Q, Tasdogan A, Petzold A, Dahl A, Arneth BM, Slany R, Fehling HJ, Kranz A, Stewart AF, Anastassiadis K
|
The H3K4 methyltransferase Setd1b is essential for hematopoietic stem and progenitor cell homeostasis in mice.
|
Elife. 2018 Jun 19;7
|
|
Developmental Biology
|

|
29916805 |
H3K4 methylation; Setd1b; conditional mutagenesis; developmental biology; hematopoietic stem and progenitor cells; mouse; regenerative medicine; stem cells |
Hematopoietic stem cells require MLL1, which is one of six Set1/Trithorax-type histone 3 lysine 4 (H3K4) methyltransferases in mammals and clinically the most important leukemia gene. Here, we add to emerging evidence that all six H3K4 methyltransferases play essential roles in the hematopoietic system by showing that conditional mutagenesis of Setd1b in adult mice provoked aberrant homeostasis of hematopoietic stem and progenitor cells (HSPCs). Using both ubiquitous and hematopoietic-specific deletion strategies, the loss of Setd1b resulted in peripheral thrombo- and lymphocytopenia, multilineage dysplasia, myeloid-biased extramedullary hematopoiesis in the spleen, and lethality. By transplantation experiments and expression profiling, we determined that Setd1b is autonomously required in the hematopoietic lineages where it regulates key lineage specification components, including Cebpa, Gata1, and Klf1. Altogether, these data imply that the Set1/Trithorax-type epigenetic machinery sustains different aspects of hematopoiesis and constitutes a second framework additional to the transcription factor hierarchy of hematopoietic homeostasis. |
|
Karbanová J, Lorico A, Bornhäuser M, Corbeil D, Fargeas CA
|
Prominin-1/CD133: Lipid Raft Association, Detergent Resistance, and Immunodetection.
|
Stem Cells Transl Med. 2018 Feb;7(2):155-160
|
|
Medical Biology
|

|
29271118 |
|
The cell surface antigen prominin-1 (alias CD133) has gained enormous interest in the past 2 decades and given rise to debates as to its utility as a biological stem and cancer stem cell marker. Important and yet often overlooked knowledge that is pertinent to its physiological function has been generated in other systems given its more general expression beyond primitive cells. This article briefly discusses the importance of particular biochemical features of CD133 with relation to its association with membrane microdomains (lipid rafts) and proper immunodetection. It also draws attention toward the adequate use of detergents and caveats that may apply to the interpretation of the results generated. |
|
Santos MF, Rappa G, Karbanová J, Kurth T, Corbeil D, Lorico A
|
VAMP-associated protein-A and oxysterol-binding protein-related protein 3 promote the entry of late endosomes into the nucleoplasmic reticulum.
|
J Biol Chem. 2018 Sep 7;293(36):13834-13848
|
|
Cell Biology
|

|
30018135 |
ORP3; VAP-A; VOR complex; cancer biology; endocytosis; endosome; exosome (vesicle); extracellular vesicles; late endosome; nuclear envelope; nuclear transport; nucleus; oxysterol-binding related protein; vesicle-associated membrane protein |
The endocytic pathway plays an instrumental role in recycling internalized molecules back to the plasma membrane or in directing them to lysosomes for degradation. We recently reported a new role of endosomes-the delivery of components from extracellular vesicles (EVs) to the nucleoplasm of recipient cells. Using indirect immunofluorescence, FRET, immunoisolation techniques, and RNAi, we report here a tripartite protein complex (referred to as the VOR complex) that is essential for the nuclear transfer of EV-derived components by orchestrating the specific localization of late endosomes into nucleoplasmic reticulum. We found that the VOR complex contains the endoplasmic reticulum-localized vesicle-associated membrane protein (VAMP)-associated protein A (VAP-A), the cytoplasmic oxysterol-binding protein-related protein 3 (ORP3), and late endosome-associated small GTPase Rab7. The silencing of VAP-A or ORP3 abrogated the association of Rab7-positive late endosomes with nuclear envelope invaginations and, hence, the transport of endocytosed EV-derived components to the nucleoplasm of recipient cells. We conclude that the VOR complex can be targeted to inhibit EV-mediated intercellular communication, which can have therapeutic potential for managing cancer in which the release of EVs is dysregulated. |
|
Thamm K, Šimaitė D, Karbanová J, Bermúdez V, Reichert D, Morgenstern A, Bornhäuser M, Huttner WB, Wilsch-Bräuninger M, Corbeil D
|
Prominin-1 (CD133) modulates the architecture and dynamics of microvilli.
|
Traffic. 2019 Jan;20(1):39-60
|
- LMF CMCB
- EMF & Histo CMCB
- EMF MPI-CBG
|
Cell Biology
|

|
30328220 |
Arp2/3 complex; CD133; epithelial cells; membrane vesicles; microvilli; phosphoinositide 3-kinase; prominin-1 |
Prominin-1 is a cell surface biomarker that allows the identification of stem and cancer stem cells from different organs. It is also expressed in several differentiated epithelial and non-epithelial cells. Irrespective of the cell type, prominin-1 is associated with plasma membrane protrusions. Here, we investigate its impact on the architecture of membrane protrusions using microvilli of Madin-Darby canine kidney cells as the main model. Our high-resolution analysis revealed that upon the overexpression of prominin-1 the number of microvilli and clusters of them increased. Microvilli with branched and/or knob-like morphologies were observed and stimulated by mutations in the ganglioside-binding site of prominin-1. The altered phenotypes were caused by the interaction of prominin-1 with phosphoinositide 3-kinase and Arp2/3 complex. Mutation of tyrosine 828 of prominin-1 impaired its phosphorylation and thereby inhibited the aforementioned interactions abolishing altered microvilli. This suggests that the interplay of prominin-1-ganglioside membrane complexes, phosphoinositide 3-kinase and cytoskeleton components regulates microvillar architecture. Lastly, the expression of prominin-1 and its mutants modified the structure of filopodia emerging from fibroblast-like cells and silencing human prominin-1 in primary hematopoietic stem cells resulted in the loss of uropod-associated microvilli. Altogether, these findings strengthen the role of prominin-1 as an organizer of cellular protrusions. |
|
Rosendahl P, Plak K, Jacobi A, Kraeter M, Toepfner N, Otto O, Herold C, Winzi M, Herbig M, Ge Y, Girardo S, Wagner K, Baum B, Guck J
|
Real-time fluorescence and deformability cytometry.
|
Nat Methods. 2018 May;15(5):355-358
|
|
Biophysics
|

|
29608556 |
|
The throughput of cell mechanical characterization has recently approached that of conventional flow cytometers. However, this very sensitive, label-free approach still lacks the specificity of molecular markers. Here we developed an approach that combines real-time 1D-imaging fluorescence and deformability cytometry in one instrument (RT-FDC), thus opening many new research avenues. We demonstrated its utility by using subcellular fluorescence localization to identify mitotic cells and test for mechanical changes in those cells in an RNA interference screen. |
|
Schlüßler R, Möllmert S, Abuhattum S, Cojoc G, Müller P, Kim K, Möckel C, Zimmermann C, Czarske J, Guck J
|
Mechanical Mapping of Spinal Cord Growth and Repair in Living Zebrafish Larvae by Brillouin Imaging.
|
Biophys J. 2018 Sep 4;115(5):911-923
|
|
Biophysics
|

|
30122291 |
|
The mechanical properties of biological tissues are increasingly recognized as important factors in developmental and pathological processes. Most existing mechanical measurement techniques either necessitate destruction of the tissue for access or provide insufficient spatial resolution. Here, we show for the first time to our knowledge a systematic application of confocal Brillouin microscopy to quantitatively map the mechanical properties of spinal cord tissues during biologically relevant processes in a contact-free and nondestructive manner. Living zebrafish larvae were mechanically imaged in all anatomical planes during development and after spinal cord injury. These experiments revealed that Brillouin microscopy is capable of detecting the mechanical properties of distinct anatomical structures without interfering with the animal's natural development. The Brillouin shift within the spinal cord remained comparable during development and transiently decreased during the repair processes after spinal cord transection. By taking into account the refractive index distribution, we explicitly determined the apparent longitudinal modulus and viscosity of different larval zebrafish tissues. Importantly, mechanical properties differed between tissues in situ and in excised slices. The presented work constitutes the first step toward an in vivo assessment of spinal cord tissue mechanics during regeneration, provides a methodical basis to identify key determinants of mechanical tissue properties, and allows us to test their relative importance in combination with biochemical and genetic factors during developmental and regenerative processes. |
|
Kräter M, Sapudom J, Bilz NC, Pompe T, Guck J, Claus C
|
Alterations in Cell Mechanics by Actin Cytoskeletal Changes Correlate with Strain-Specific Rubella Virus Phenotypes for Cell Migration and Induction of Apoptosis.
|
Cells. 2018 Sep 13;7(9)
|
|
Cell Biology
|

|
30217036 |
actin stress fibers; cell stiffness; cytochalasin D; gap closure assay; real-time deformability cytometry; single cell tracking; wound healing |
The cellular cytoskeleton is central for key cellular functions, and as such is a marker for diseased and infected cell states. Here we analyzed infection with rubella virus (RV) strains with respect to phenotypes in cellular mechanical properties, cell movement, and viral cytopathogenicity. Real-time deformability cytometry (RT-DC), as a high-throughput platform for the assessment of cell mechanics, revealed a correlation of an increase in cortical filamentous-actin (F-actin) with a higher cellular stiffness. The additional reduction of stress fibers noted for only some RV strains as the most severe actin rearrangement lowered cell stiffness. Furthermore, a reduced collective and single cell migration speed in a wound healing assay was detected in addition to severe changes in cell morphology. The latter was followed by activation of caspase 3/7 as a sign for induction of apoptosis. Our study emphasizes RT-DC technology as a sensitive means to characterize viral cell populations and to implicate alterations of cell mechanical properties with cell functions. These interdependent events are not only promising options to elucidate viral spread and to understand viral pathologies within the infected host. They also contribute to any diseased cell state, as exemplified by RV as a representative agent for cytoskeletal alterations involved in a cytopathological outcome. |
|
Pawolski D, Heintze C, Mey I, Steinem C, Kröger N
|
Reconstituting the formation of hierarchically porous silica patterns using diatom biomolecules.
|
J Struct Biol. 2018 Oct;204(1):64-74
|
|
Biomaterials
|

|
30009877 |
Biomineralization; Biosilica; Long-chain polyamines; Morphogenesis; Organic matrix; Self-assembly |
The genetically-controlled formation of complex-shaped inorganic materials by living organisms is an intriguing phenomenon. It illustrates our incomplete understanding of biological morphogenesis and demonstrates the feasibility of ecologically benign routes for materials technology. Amorphous SiO2 (silica) is taxonomically the most widespread biomineral, with diatoms, a large group of single-celled microalgae, being the most prolific producers. Silica is the main component of diatom cell walls, which exhibit species-specific patterns of pores that are hierarchically arranged and endow the material with advantageous properties. Despite recent advances in characterizing diatom biomolecules involved in biosilica morphogenesis, the mechanism of this process has remained controversial. Here we describe the in vitro synthesis of diatom-like, porous silica patterns using organic components that were isolated from biosilica of the diatom Cyclotella cryptica. The synthesis relies on the synergism of soluble biomolecules (long-chain polyamines and proteins) with an insoluble nanopatterned organic matrix. Biochemical dissection of the process revealed that the long-chain polyamines rather than the proteins are essential for efficient in vitro synthesis of the hierarchically porous silica patterns. Our results support the organic matrix hypothesis for morphogenesis of diatom biosilica and introduce organic matrices from diatoms as a new tool for the synthesis of meso- to microporous inorganic materials. |
|
Kurth T, Kretschmar S, Buttstedt A
|
Royal jelly in focus
|
Insect. Soc. (2018)
|
|
|

|
|
MRJP, Queen determination, Social insect, Structural protein, Protein fibril |
Honey bee (Apis spp.) royal jelly, a glandular secretion used to raise young larvae to future queens, has long been considered merely as food. Since queen larvae are raised upside down in their vertically oriented queen cells, royal jelly also needs to adhere the larvae to the cell ceiling to prevent the prospective queen from dropping out. This is exactly where the native acidic pH of royal jelly comes into play: only at a pH of 4.0 is royal jelly viscous enough to hold the larvae in their cells. We here show with the help of electron microscopy that royal jelly possesses a complex tissue-like organization at pH 4.0 which is similar to the dense extracellular matrix of animals providing structural support. The main structural elements at pH 4.0 are proteinaceous fibril bundles, embedded in a fibrillary net, that seem to be bunched in electron-dense structures, potential sites of fibril overlap and cross-linking. At an exogenously induced increased royal jelly pH of 7.0, these fibrillary structures are largely destroyed. This is when royal jelly viscosity decreases and holding the queen larvae in place is no longer guaranteed. |
|
Vogler S, Prokoph S, Freudenberg U, Binner M, Tsurkan M, Werner C, Kempermann G
|
Defined Geldrop Cultures Maintain Neural Precursor Cells.
|
Sci Rep. 2018 May 30;8(1):8433
|
|
Neurobiology
|

|
29849044 |
|
Distinct micro-environmental properties have been reported to be essential for maintenance of neural precursor cells (NPCs) within the adult brain. Due to high complexity and technical limitations, the natural niche can barely be studied systematically in vivo. By reconstituting selected environmental properties (adhesiveness, proteolytic degradability, and elasticity) in geldrop cultures, we show that NPCs can be maintained stably at high density over an extended period of time (up to 8 days). In both conventional systems, neurospheres and monolayer cultures, they would expand and (in the case of neurospheres) differentiate rapidly. Further, we report a critical dualism between matrix adhesiveness and degradability. Only if both features are functional NPCs stay proliferative. Lastly, Rho-associated protein kinase was identified as part of a pivotal intracellular signaling cascade controlling cell morphology in response to environmental cues inside geldrop cultures. Our findings demonstrate that simple manipulations of the microenvironment in vitro result in an important preservation of stemness features in the cultured precursor cells. |
|
Schoeppler V, Gránásy L, Reich E, Poulsen N, de Kloe R, Cook P, Rack A, Pusztai T, Zlotnikov I
|
Biomineralization as a Paradigm of Directional Solidification: A Physical Model for Molluscan Shell Ultrastructural Morphogenesis.
|
Adv Mater. 2018 Nov;30(45)
|
|
Biomaterials
|

|
30239045 |
biomineralization; crystal growth; mollusc shells; phase-field modeling; solidification |
Molluscan shells are a model system to understand the fundamental principles of mineral formation by living organisms. The diversity of unconventional mineral morphologies and 3D mineral-organic architectures that comprise these tissues, in combination with their exceptional mechanical efficiency, offers a unique platform to study the formation-structure-function relationship in a biomineralized system. However, so far, morphogenesis of these ultrastructures is poorly understood. Here, a comprehensive physical model, based on the concept of directional solidification, is developed to describe molluscan shell biomineralization. The capacity of the model to define the forces and thermodynamic constraints that guide the morphogenesis of the entire shell construct-the prismatic and nacreous ultrastructures and their transitions-and govern the evolution of the constituent mineralized assemblies on the ultrastructural and nanostructural levels is demonstrated using the shell of the bivalve Unio pictorum. Thereby, explicit tools for novel bioinspired and biomimetic bottom-up materials design are provided. |
|
Thomas AK, Wieduwild R, Zimmermann R, Lin W, Friedrichs J, Bickle M, Fahmy K, Werner C, Zhang Y
|
Layer-by-Layer Assembly of Heparin and Peptide-Polyethylene Glycol Conjugates to Form Hybrid Nanothin Films of Biomatrices.
|
ACS Appl Mater Interfaces. 2018 May 2;10(17):14264-14270
|
|
Applied Chemistry
|

|
29658265 |
biomimetic; extracellular matrix; heparin; layer-by-layer; nano thin |
We investigated the utility of a heparin/peptide-polyethylene glycol conjugate system to build layer-by-layer (LbL) structures, to assemble tailored multilayer-biomatrices for cell culture. The LbL assembly balances the advantages of polyelectrolyte systems and protein-based systems. Human umbilical vein endothelial cells showed distinct responses to the film thickness and structure; the presence, density, and spatial arrangement of a cell adhesion ligand within the nanothin film; and the pretreatment of the film with morphogens. The LbL technique presents a versatile tool for modifying cell culture substrates with defined and diverse biochemical and structural features, for investigating cell-material interactions. |
|
Wieduwild R, Wetzel R, Husman D, Bauer S, El-Sayed I, Duin S, Murawala P, Thomas AK, Wobus M, Bornhäuser M, Zhang Y
|
Coacervation-Mediated Combinatorial Synthesis of Biomatrices for Stem Cell Culture and Directed Differentiation.
|
Adv Mater. 2018 May;30(22)
|
- LMF DZNE
- EMF & Histo CMCB
|
Biomaterials
|

|
29659062 |
coacervation; glycosaminoglycans; material screening; peptides; stem cells |
Combinatorial screening represents a promising strategy to discover biomaterials for tailored cell culture applications. Although libraries incorporating different biochemical cues have been investigated, few simultaneously recapitulate relevant biochemical, physical, and dynamic features of the extracellular matrix (ECM). Here, a noncovalent system based on liquid-liquid phase separation (coacervation) and gelation mediated by glycosaminoglycan (GAG)-peptide interactions is reported. Multiple biomaterial libraries are generated using combinations of sulfated glycosaminoglycans and poly(ethylene glycol)-conjugated peptides. Screening these biomaterials reveals preferred biomatrices for the attachment of six cell types, including primary mesenchymal stromal cells (MSCs) and primary neural precursor cells (NPCs). Incorporation of GAGs sustains the expansion of all tested cell types comparable to standard cell culture surfaces, while osteogenic differentiation of MSC and neuronal differentiation of NPC are promoted on chondroitin and heparan biomatrices, respectively. The presented noncovalent system provides a powerful tool for developing tissue-specific ECM mimics. |
|
Sui L, Alt S, Weigert M, Dye N, Eaton S, Jug F, Myers EW, Jülicher F, Salbreux G, Dahmann C
|
Differential lateral and basal tension drive folding of Drosophila wing discs through two distinct mechanisms.
|
Nat Commun. 2018 Nov 5;9(1):4620
|
|
Biophysics
|

|
30397306 |
|
Epithelial folding transforms simple sheets of cells into complex three-dimensional tissues and organs during animal development. Epithelial folding has mainly been attributed to mechanical forces generated by an apically localized actomyosin network, however, contributions of forces generated at basal and lateral cell surfaces remain largely unknown. Here we show that a local decrease of basal tension and an increased lateral tension, but not apical constriction, drive the formation of two neighboring folds in developing Drosophila wing imaginal discs. Spatially defined reduction of extracellular matrix density results in local decrease of basal tension in the first fold; fluctuations in F-actin lead to increased lateral tension in the second fold. Simulations using a 3D vertex model show that the two distinct mechanisms can drive epithelial folding. Our combination of lateral and basal tension measurements with a mechanical tissue model reveals how simple modulations of surface and edge tension drive complex three-dimensional morphological changes. |
|
Prince E, Kroeger B, Gligorov D, Wilson C, Eaton S, Karch F, Brankatschk M, Maeda RK
|
Rab-mediated trafficking in the secondary cells of Drosophila male accessory glands and its role in fecundity.
|
Traffic. 2019 Feb;20(2):137-151
|
|
Cell Biology
|

|
30426623 |
Drosophila melanogaster; Rab19; Rab6; confocal microscopy; male accessory glands; postmating response; vacuole-like compartments |
The male seminal fluid contains factors that affect female post-mating behavior and physiology. In Drosophila, most of these factors are secreted by the two epithelial cell types that make up the male accessory gland: the main and secondary cells. Although secondary cells represent only ~4% of the cells of the accessory gland, their contribution to the male seminal fluid is essential for sustaining the female post-mating response. To better understand the function of the secondary cells, we investigated their molecular organization, particularly with respect to the intracellular membrane transport machinery. We determined that large vacuole-like structures found in the secondary cells are trafficking hubs labeled by Rab6, 7, 11 and 19. Furthermore, these organelles require Rab6 for their formation and many are essential in the process of creating the long-term postmating behavior of females. In order to better serve the intracellular membrane and protein trafficking communities, we have created a searchable, online, open-access imaging resource to display our complete findings regarding Rab localization in the accessory gland. |
|
Kalebic N, Gilardi C, Albert M, Namba T, Long KR, Kostic M, Langen B, Huttner WB
|
Human-specific ARHGAP11B induces hallmarks of neocortical expansion in developing ferret neocortex.
|
Elife. 2018 Nov 28;7
|
|
Neurobiology
|

|
30484771 |
ARHGAP11B; developmental biology; ferret; neocortex development; neocortex evolution; neuroscience |
The evolutionary increase in size and complexity of the primate neocortex is thought to underlie the higher cognitive abilities of humans. ARHGAP11B is a human-specific gene that, based on its expression pattern in fetal human neocortex and progenitor effects in embryonic mouse neocortex, has been proposed to have a key function in the evolutionary expansion of the neocortex. Here, we study the effects of ARHGAP11B expression in the developing neocortex of the gyrencephalic ferret. In contrast to its effects in mouse, ARHGAP11B markedly increases proliferative basal radial glia, a progenitor cell type thought to be instrumental for neocortical expansion, and results in extension of the neurogenic period and an increase in upper-layer neurons. Consequently, the postnatal ferret neocortex exhibits increased neuron density in the upper cortical layers and expands in both the radial and tangential dimensions. Thus, human-specific ARHGAP11B can elicit hallmarks of neocortical expansion in the developing ferret neocortex. |
|
Singer D, Thamm K, Zhuang H, Karbanová J, Gao Y, Walker JV, Jin H, Wu X, Coveney CR, Marangoni P, Lu D, Grayson PRC, Gulsen T, Liu KJ, Ardu S, Wann AK, Luo S, Zambon AC, Jetten AM, Tredwin C, Klein OD, Attanasio M, Carmeliet P, Huttner WB, Corbeil D, Hu B
|
Prominin-1 controls stem cell activation by orchestrating ciliary dynamics.
|
EMBO J. 2019 Jan 15;38(2)
|
|
Cell Biology
|

|
30523147 |
CD133; cilia; sonic hedgehog; stem cells; tooth |
Proper temporal and spatial activation of stem cells relies on highly coordinated cell signaling. The primary cilium is the sensory organelle that is responsible for transmitting extracellular signals into a cell. Primary cilium size, architecture, and assembly-disassembly dynamics are under rigid cell cycle-dependent control. Using mouse incisor tooth epithelia as a model, we show that ciliary dynamics in stem cells require the proper functions of a cholesterol-binding membrane glycoprotein, Prominin-1 (Prom1/CD133), which controls sequential recruitment of ciliary membrane components, histone deacetylase, and transcription factors. Nuclear translocation of Prom1 and these molecules is particularly evident in transit amplifying cells, the immediate derivatives of stem cells. The absence of Prom1 impairs ciliary dynamics and abolishes the growth stimulation effects of sonic hedgehog (SHH) treatment, resulting in the disruption of stem cell quiescence maintenance and activation. We propose that Prom1 is a key regulator ensuring appropriate response of stem cells to extracellular signals, with important implications for development, regeneration, and diseases. |
|
Weigert M, Schmidt U, Boothe T, Müller A, Dibrov A, Jain A, Wilhelm B, Schmidt D, Broaddus C, Culley S, Rocha-Martins M, Segovia-Miranda F, Norden C, Henriques R, Zerial M, Solimena M, Rink J, Tomancak P, Royer L, Jug F, Myers EW
|
Content-aware image restoration: pushing the limits of fluorescence microscopy.
|
Nat Methods. 2018 Dec;15(12):1090-1097
|
|
Image Processing
|

|
30478326 |
|
Fluorescence microscopy is a key driver of discoveries in the life sciences, with observable phenomena being limited by the optics of the microscope, the chemistry of the fluorophores, and the maximum photon exposure tolerated by the sample. These limits necessitate trade-offs between imaging speed, spatial resolution, light exposure, and imaging depth. In this work we show how content-aware image restoration based on deep learning extends the range of biological phenomena observable by microscopy. We demonstrate on eight concrete examples how microscopy images can be restored even if 60-fold fewer photons are used during acquisition, how near isotropic resolution can be achieved with up to tenfold under-sampling along the axial direction, and how tubular and granular structures smaller than the diffraction limit can be resolved at 20-times-higher frame rates compared to state-of-the-art methods. All developed image restoration methods are freely available as open source software in Python, FIJI, and KNIME. |
|
Jordan MA, Diener DR, Stepanek L, Pigino G
|
The cryo-EM structure of intraflagellar transport trains reveals how dynein is inactivated to ensure unidirectional anterograde movement in cilia.
|
Nat Cell Biol. 2018 Nov;20(11):1250-1255
|
|
Cell Biology
|
|
30323187 |
|
Movement of cargos along microtubules plays key roles in diverse cellular processes, from signalling to mitosis. In cilia, rapid movement of ciliary components along the microtubules to and from the assembly site is essential for the assembly and disassembly of the structure itself1. This bidirectional transport, known as intraflagellar transport (IFT)2, is driven by the anterograde motor kinesin-23 and the retrograde motor dynein-1b (dynein-2 in mammals)4,5. However, to drive retrograde transport, dynein-1b must first be delivered to the ciliary tip by anterograde IFT6. Although, the presence of opposing motors in bidirectional transport processes often leads to periodic stalling and slowing of cargos7, IFT is highly processive1,2,8. Using cryo-electron tomography, we show that a tug-of-war between kinesin-2 and dynein-1b is prevented by loading dynein-1b onto anterograde IFT trains in an autoinhibited form and by positioning it away from the microtubule track to prevent binding. Once at the ciliary tip, dynein-1b must transition into an active form and engage microtubules to power retrograde trains. These findings provide a striking example of how coordinated structural changes mediate the behaviour of complex cellular machinery. |
|
Singh SP, Janjuha S, Chaudhuri S, Reinhardt S, Kränkel A, Dietz S, Eugster A, Bilgin H, Korkmaz S, Zararsız G, Ninov N, Reid JE
|
Machine learning based classification of cells into chronological stages using single-cell transcriptomics.
|
Sci Rep. 2018 Nov 21;8(1):17156
|
|
Image Processing
|

|
30464314 |
|
Age-associated deterioration of cellular physiology leads to pathological conditions. The ability to detect premature aging could provide a window for preventive therapies against age-related diseases. However, the techniques for determining cellular age are limited, as they rely on a limited set of histological markers and lack predictive power. Here, we implement GERAS (GEnetic Reference for Age of Single-cell), a machine learning based framework capable of assigning individual cells to chronological stages based on their transcriptomes. GERAS displays greater than 90% accuracy in classifying the chronological stage of zebrafish and human pancreatic cells. The framework demonstrates robustness against biological and technical noise, as evaluated by its performance on independent samplings of single-cells. Additionally, GERAS determines the impact of differences in calorie intake and BMI on the aging of zebrafish and human pancreatic cells, respectively. We further harness the classification ability of GERAS to identify molecular factors that are potentially associated with the aging of beta-cells. We show that one of these factors, junba, is necessary to maintain the proliferative state of juvenile beta-cells. Our results showcase the applicability of a machine learning framework to classify the chronological stage of heterogeneous cell populations, while enabling detection of candidate genes associated with aging. |
|
Körholz JC, Zocher S, Grzyb AN, Morisse B, Poetzsch A, Ehret F, Schmied C, Kempermann G
|
Selective increases in inter-individual variability in response to environmental enrichment in female mice.
|
Elife. 2018 Oct 26;7
|
|
Neurobiology
|

|
30362941 |
Adult neurogenesis; Enriched environment; behavior; hippocampus; mouse; neuroscience; plasticity; variance |
One manifestation of individualization is a progressively differential response of individuals to the non-shared components of the same environment. Individualization has practical implications in the clinical setting, where subtle differences between patients are often decisive for the success of an intervention, yet there has been no suitable animal model to study its underlying biological mechanisms. Here we show that enriched environment (ENR) can serve as a model of brain individualization. We kept 40 isogenic female C57BL/6JRj mice for 3 months in ENR and compared these mice to an equally sized group of standard-housed control animals, looking at the effects on a wide range of phenotypes in terms of both means and variances. Although ENR influenced multiple parameters and restructured correlation patterns between them, it only increased differences among individuals in traits related to brain and behavior (adult hippocampal neurogenesis, motor cortex thickness, open field and object exploration), in agreement with the hypothesis of a specific activity-dependent development of brain individuality. |
|
Xu Y, Yang X, Thomas AK, Patsis PA, Kurth T, Kräter M, Eckert K, Bornhäuser M, Zhang Y.
|
Noncovalently Assembled Electroconductive Hydrogel.
|
ACS Appl Mater Interfaces. 2018 May 2;10(17):14418-14425
|
- LMF CMCB
- LMF DZNE
- EMF & Histo CMCB
|
Biomaterials
|

|
29644843 |
3D cell culture; PEDOT:PSS; electrical stimulation; electroconductive hydrogel; peptide; self-assembling |
Cross-linking biomolecules with electroconductive nanostructures through noncovalent interactions can result in modular networks with defined biological functions and physical properties such as electric conductivity and viscoelasticity. Moreover, the resulting matrices can exhibit interesting features caused by the dynamic assembly process, such as self-healing and molecular ordering. In this paper, we present a physical hydrogel system formed by mixing peptide-polyethylene glycol and poly(3,4-ethylenedioxythiophene):polystyrene sulfonate. This combinatorial approach, which uses different modular building blocks, could lead to high tunability on aspects of rheology and electrical impedance. The proposed physical hydrogel system is characterized by both a self-healing ability and injectability. Interestingly, the formation of hydrogels at relatively low concentrations led to a network of closer molecular packing of poly(3,4-ethylenedioxythiophene) nanoparticles, reflected by the enhanced conductivity. The biopolymer system can be used to develop three-dimensional cell cultures with incorporated electric stimuli, as evidenced by its contribution to the survival and proliferation of encapsulated mesenchymal stromal cells and their differentiation upon electrical stimulation. |
|
Long KR, Newland B, Florio M, Kalebic N, Langen B, Kolterer A, Wimberger P, Huttner WB
|
Extracellular Matrix Components HAPLN1, Lumican, and Collagen I Cause Hyaluronic Acid-Dependent Folding of the Developing Human Neocortex.
|
Neuron. 2018 Aug 22;99(4):702-719
|
|
Neurobiology
|

|
30078576 |
ECM; HAPLN1; Human neocortex; collagen; hyaluronic acid; lumican; neocortex development; neocortex folding; neurodevelopmental disorders |
Neocortical expansion, thought to underlie the cognitive traits unique to humans, is accompanied by cortical folding. This folding starts around gestational week (GW) 20, but what causes it remains largely unknown. Extracellular matrix (ECM) has been previously implicated in neocortical expansion and here we investigate the potential role of ECM in the formation of neocortical folds. We focus on three specific ECM components localized in the human fetal cortical plate (CP): hyaluronan and proteoglycan link protein 1 (HAPLN1), lumican and collagen I (collectively, HLC). Addition of HLC to cultures of human fetal neocortex (11-22 GW) caused local changes in tissue stiffness, induced CP folding, increased CP hyaluronic acid (HA), and required the HA-receptor CD168 and downstream ERK signaling. Importantly, loss of HA reduced HLC-induced and 22 GW physiological nascent folds. This was altered in samples with neurodevelopmental disorders, indicating it may be a useful system to study such disorders. |
|
Tavano S, Taverna E, Kalebic N, Haffner C, Namba T, Dahl A, Wilsch-Bräuninger M, Paridaen JTML, Huttner WB
|
Insm1 Induces Neural Progenitor Delamination in Developing Neocortex via Downregulation of the Adherens Junction Belt-Specific Protein Plekha7.
|
Neuron. 2018 Mar 21;97(6):1299-1314
|
|
Neurobiology
|

|
29503187 |
AJ belt disassembly; Insm1; NPC delamination; Plekha7; basal progenitors; basal radial glia; subventricular zone |
Delamination of neural progenitor cells (NPCs) from the ventricular surface is a crucial prerequisite to form the subventricular zone, the germinal layer linked to the expansion of the mammalian neocortex in development and evolution. Here, we dissect the molecular mechanism by which the transcription factor Insm1 promotes the generation of basal progenitors (BPs). Insm1 protein is most highly expressed in newborn BPs in mouse and human developing neocortex. Forced Insm1 expression in embryonic mouse neocortex causes NPC delamination, converting apical to basal radial glia. Insm1 represses the expression of the apical adherens junction belt-specific protein Plekha7. CRISPR/Cas9-mediated disruption of Plekha7 expression suffices to cause NPC delamination. Plekha7 overexpression impedes the intrinsic and counteracts the Insm1-induced, NPC delamination. Our findings uncover a novel molecular mechanism underlying NPC delamination in which a BP-genic transcription factor specifically targets the integrity of the apical adherens junction belt, rather than adherens junction components as such. |
|
Wang J, Choi JM, Holehouse AS, Lee HO, Zhang X, Jahnel M, Maharana S, Lemaitre R, Pozniakovsky A, Drechsel D, Poser I, Pappu RV, Alberti S, Hyman AA
|
A Molecular Grammar Governing the Driving Forces for Phase Separation of Prion-like RNA Binding Proteins.
|
Cell. 2018 Jul 26;174(3):688-699
|
|
Cell Biology
|

|
29961577 |
FUS; PLD; cation-π; intrinsically disordered; low complexity; membraneless compartments; phase separation; prion-like; prion-like RNA binding proteins; saturation concentration |
Proteins such as FUS phase separate to form liquid-like condensates that can harden into less dynamic structures. However, how these properties emerge from the collective interactions of many amino acids remains largely unknown. Here, we use extensive mutagenesis to identify a sequence-encoded molecular grammar underlying the driving forces of phase separation of proteins in the FUS family and test aspects of this grammar in cells. Phase separation is primarily governed by multivalent interactions among tyrosine residues from prion-like domains and arginine residues from RNA-binding domains, which are modulated by negatively charged residues. Glycine residues enhance the fluidity, whereas glutamine and serine residues promote hardening. We develop a model to show that the measured saturation concentrations of phase separation are inversely proportional to the product of the numbers of arginine and tyrosine residues. These results suggest it is possible to predict phase-separation properties based on amino acid sequences. |
|
Shevchenko A, Schuhmann A, Thomas H, Wetzel G
|
Fine Endmesolithic fish caviar meal discovered by proteomics in foodcrusts from archaeological site Friesack 4 (Brandenburg, Germany).
|
PLoS One. 2018 Nov 28;13(11)
|
|
Biochemistry
|

|
30485287 |
|
The role of aquatic resources in ancient economies and paleodiet is important for understanding the evolution of prehistorical societies. Charred food remains from ancient pottery are valuable molecular evidence of dietary habits in antiquity. However, conventional archaeometric approaches applied in their analysis lack organismal specificity, are affected by abundant environmental contaminants, do not elucidate food processing recipes and are limited in the inland regions where diverse dietary resources are available. We performed proteomics analysis of charred organic deposits adhered on early ceramics from Mesolithic-Neolithic inland site Friesack 4 (Brandenburg, Germany). One of pots-a small coarse bowl radiocarbon dated to the end of the 5th millennium BC-was attributed to Endmesolithic pottery. Proteomics of foodcrust from this vessel identified fine carp roe meal and revealed details of a prehistorical culinary recipe. Ancient proteins were unequivocally distinguished from contemporary contaminants by computing deamidation ratios of glutamine residues. These data paint a broader picture of the site-specific exploitation of aquatic resources and contribute to better understanding of the dietary context of Neolithic transition in European inland. |
|
Walch L, Pellier E, Leng W, Lakisic G, Gautreau A, Contremoulins V, Verbavatz JM, Jackson CL
|
GBF1 and Arf1 interact with Miro and regulate mitochondrial positioning within cells.
|
Sci Rep. 2018 Nov 20;8(1)
|
|
Cell Biology
|

|
30459446 |
|
The spatial organization of cells depends on coordination between cytoskeletal systems and intracellular organelles. The Arf1 small G protein and its activator GBF1 are important regulators of Golgi organization, maintaining its morphology and function. Here we show that GBF1 and its substrate Arf1 regulate the spatial organization of mitochondria in a microtubule-dependent manner. Miro is a mitochondrial membrane protein that interacts through adaptors with microtubule motor proteins such as cytoplasmic dynein, the major microtubule minus end directed motor. We demonstrate a physical interaction between GBF1 and Miro, and also between the active GTP-bound form of Arf1 and Miro. Inhibition of GBF1, inhibition of Arf1 activation, or overexpression of Miro, caused a collapse of the mitochondrial network towards the centrosome. The change in mitochondrial morphology upon GBF1 inhibition was due to a two-fold increase in the time engaged in retrograde movement compared to control conditions. Electron tomography revealed that GBF1 inhibition also resulted in larger mitochondria with more complex morphology. Miro silencing or drug inhibition of cytoplasmic dynein activity blocked the GBF1-dependent repositioning of mitochondria. Our results show that blocking GBF1 function promotes dynein- and Miro-dependent retrograde mitochondrial transport along microtubules towards the microtubule-organizing center, where they form an interconnected network. |
|
Zuber R, Norum M, Wang Y, Oehl K, Gehring N, Accardi D, Bartozsewski S, Berger J, Flötenmeyer M, Moussian B
|
The ABC transporter Snu and the extracellular protein Snsl cooperate in the formation of the lipid-based inward and outward barrier in the skin of Drosophila.
|
Eur J Cell Biol. 2018 Mar;97(2):90-101
|
|
Cell Biology
|

|
29306642 |
|
Lipids in extracellular matrices (ECM) contribute to barrier function and stability of epithelial tissues such as the pulmonary alveoli and the skin. In insects, skin waterproofness depends on the outermost layer of the extracellular cuticle termed envelope that contains cuticulin, an unidentified water-repellent complex molecule composed of proteins, lipids and catecholamines. Based on live-imaging analyses of fruit fly larvae, we find that initially envelope units are assembled within putative vesicles harbouring the ABC transporter Snu and the extracellular protein Snsl. In a second step, the content of these vesicles is distributed to cuticular lipid-transporting nanotubes named pore canals and to the cuticle surface in dependence of Snu function. Consistently, the surface of snu and snsl mutant larvae is depleted from lipids and cuticulin. By consequence, these animals suffer uncontrolled water loss and penetration of xenobiotics. Our data allude to a two-step model of envelope i.e. barrier formation. The proposed mechanism in principle parallels the events occurring during differentiation of the lipid-based ECM by keratinocytes in the vertebrate skin suggesting establishment of analogous mechanisms of skin barrier formation in vertebrates and invertebrates. |
|
Nikolakopoulou P, Chatzigeorgiou A, Kourtzelis I, Toutouna L, Masjkur J, Arps-Forker C, Poser SW, Rozman J, Rathkolb B, Aguilar-Pimentel JA; German Mouse Clinic Consortium, Wolf E, Klingenspor M, Ollert M, Schmidt-Weber C, Fuchs H, Gailus-Durner V, Hrabe de Angelis M, Tsata V, Monasor LS, Troullinaki M, Witt A, Anastasiou V, Chrousos G, Yi CX, García-Cáceres C, Tschöp MH, Bornstein SR, Androutsellis-Theotokis A
|
Streptozotocin-induced β-cell damage, high fat diet, and metformin administration regulate Hes3 expression in the adult mouse brain.
|
Sci Rep. 2018 Jul 27;8(1):11335
|
|
Medical Biology
|

|
30054579 |
|
Diabetes mellitus is a group of disorders characterized by prolonged high levels of circulating blood glucose. Type 1 diabetes is caused by decreased insulin production in the pancreas whereas type 2 diabetes may develop due to obesity and lack of exercise; it begins with insulin resistance whereby cells fail to respond properly to insulin and it may also progress to decreased insulin levels. The brain is an important target for insulin, and there is great interest in understanding how diabetes affects the brain. In addition to the direct effects of insulin on the brain, diabetes may also impact the brain through modulation of the inflammatory system. Here we investigate how perturbation of circulating insulin levels affects the expression of Hes3, a transcription factor expressed in neural stem and progenitor cells that is involved in tissue regeneration. Our data show that streptozotocin-induced β-cell damage, high fat diet, as well as metformin, a common type 2 diabetes medication, regulate Hes3 levels in the brain. This work suggests that Hes3 is a valuable biomarker helping to monitor the state of endogenous neural stem and progenitor cells in the context of diabetes mellitus. |
|
Egners A, Rezaei M, Kuzmanov A, Poitz DM, Streichert D, Müller-Reichert T, Wielockx B, Breier G
|
PHD3 Acts as Tumor Suppressor in Mouse Osteosarcoma and Influences Tumor Vascularization via PDGF-C Signaling.
|
Cancers (Basel). 2018 Dec 6;10(12)
|
|
Medical Biology
|

|
30563292 |
PDGF-C; PDGFR-α; prolyl hydroxylase domain protein; tumor angiogenesis; tumor progression |
Cancer cell proliferation and insufficient blood supply can lead to the development of hypoxic areas in the tumor tissue. The adaptation to the hypoxic environment is mediated by a transcriptional complex called hypoxia-inducible factor (HIF). HIF protein levels are tightly controlled by oxygen-dependent prolyl hydroxylase domain proteins (PHDs). However, the precise roles of these enzymes in tumor progression and their downstream signaling pathways are not fully characterized. Here, we study PHD3 function in murine experimental osteosarcoma. Unexpectedly, PHD3 silencing in LM8 cells affects neither HIF-1α protein levels, nor the expression of various HIF-1 target genes. Subcutaneous injection of PHD3-silenced tumor cells accelerated tumor progression and was accompanied by dramatic phenotypic changes in the tumor vasculature. Blood vessels in advanced PHD3-silenced tumors were enlarged whereas their density was greatly reduced. Examination of the molecular pathways underlying these alterations revealed that platelet-derived growth factor (PDGF)-C signaling is activated in the vasculature of PHD3-deficient tumors. Silencing of PDGF-C depleted tumor growth, increased vessel density and reduced vessel size. Our data show that PHD3 controls tumor growth and vessel architecture in LM8 osteosarcoma by regulating the PDGF-C pathway, and support the hypothesis that different members of the PHD family exert unique functions in tumors. |
|
Pal A, Glaß H, Naumann M, Kreiter N, Japtok J, Sczech R, Hermann A
|
High content organelle trafficking enables disease state profiling as powerful tool for disease modelling.
|
Sci Data. 2018 Nov 13;5:180241
|
|
Medical Biology
|

|
30422121 |
|
Neurodegenerative diseases pose a complex field with various neuronal subtypes and distinct differentially affected intra-neuronal compartments. Modelling of neurodegeneration requires faithful in vitro separation of axons and dendrites, their distal and proximal compartments as well as organelle tracking with defined retrograde versus anterograde directionality. We use microfluidic chambers to achieve compartmentalization and established high throughput live organelle imaging at standardized distal and proximal axonal readout sites in iPSC-derived spinal motor neuron cultures from human amyotrophic lateral sclerosis patients to study trafficking phenotypes of potential disease relevance. Our semi-automated pipeline of organelle tracking with FIJI and KNIME yields quantitative, multiparametric high content phenotypic signatures of organelle morphology and their trafficking in axons. We provide here the resultant large datasets to enable systemic signature interrogations for comprehensive and predictive disease modelling, mechanistic dissection and secondary hit validation (e.g. drug screens, genetic screens). Due to the nearly complete coverage of analysed motility events, our quantitative method yields a bias-free statistical power superior over common analyses of a handful of manual kymographs. |
|
Dittfeld C, Reimann G, Mieting A, Büttner P, Jannasch A, Plötze K, Steiner G, Tugtekin SM, Matschke K
|
Treatment with XAV-939 prevents in vitro calcification of human valvular interstitial cells.
|
PLoS One. 2018 Dec 7;13(12)
|
|
Medical Biology
|

|
30532256 |
|
The development of a substance or inhibitor-based treatment strategy for the prevention of aortic valve stenosis is a challenge and a main focus of medical research in this area. One strategy may be to use the tankyrase inhibitor XAV-939, which leads to Axin stabilisation and subsequent destruction of the β-catenin complex and dephosphorylation of β-catenin. The dephosphorylated active form of β-catenin (non-phospho-β-catenin) then promotes nuclear transcription that leads to osteogenesis. The aims of the present study were to develop an experimental system for inducing in vitro calcification of human aortic valvular interstitial cells (VICs) to investigate the potential anti-calcific effect of XAV-939 and to analyse expression of the Wnt signalling proteins and Sox9, a chondrogenesis regulator, in this model. Calcification of human VIC cultures was induced by cultivation in an osteogenic medium and the effect of co-incubation with 1μM XAV-939 was monitored. Calcification was quantified when mineral deposits were visible in culture and was histologically verified by von Kossa or Alizarin red staining and by IR-spectroscopy. Protein expression of alkaline phosphatase, Axin, β-catenin and Sox9 were quantified by western blotting. In 58% of the VIC preparations, calcification was induced in an osteogenic culture medium and was accompanied by upregulation of alkaline phosphatase. The calcification induction was prevented by the XAV-939 co-treatment and the alkaline phosphatase upregulation was suppressed. As expected, Axin was upregulated, but the levels of active non-phospho-β-catenin were also enhanced. Sox9 was induced during XAV-939 treatment but apparently not as a result of downregulation of β-catenin signalling. XAV-939 was therefore able to prevent calcification of human VIC cultures, and XAV-939 treatment was accompanied by upregulation of active non-phospho-β-catenin. Although XAV-939 does not downregulate active β-catenin, treatment with XAV-939 results in Sox9 upregulation that may prevent the calcification process. |
|
Kreiter N, Pal A, Lojewski X, Corcia P, Naujock M, Reinhardt P, Sterneckert J, Petri S, Wegner F, Storch A, Hermann A
|
Age-dependent neurodegeneration and organelle transport deficiencies in mutant TDP43 patient-derived neurons are independent of TDP43 aggregation.
|
Neurobiol Dis. 2018 Jul;115:167-181
|
|
Medical Biology
|

|
29630989 |
Amyotrophic lateral sclerosis; Axonopathy; DNA damage; Live cell imaging; Lysosomes; Mitochondria; Neurodegeneration; Neurofilament; Nuclear stress; TAR DNA binding protein 43; TARDBP; hnRNPK |
TAR DNA-binding protein 43 (TDP43) plays a significant role in familiar and sporadic amyotrophic lateral sclerosis (ALS). The diverse postulated mechanisms by which TDP43 mutations cause the disease are not fully understood. Human wildtype and TDP43 S393L and G294V mutant spinal motor neuron cultures were differentiated from patient-derived iPSCs. Mutant hTDP43 and wildtype motor neuron cultures did not differ in neuron differentiation capacity during early maturation stage. During aging we detected a dramatic neurodegeneration including neuron loss and pathological neurofilament abnormalities only in TDP43 mutant cultures. Additionally mitochondria and lysosomes of aging spinal motor neurons revealed robust TDP43 mutation dependent abnormal phenotypes in size, shape, speed and motility which all appeared without TDP43 mislocalization or aggregation formation. Furthermore, D-sorbitol - known to induce stress granules and cytoplasmic mislocalization of TDP43 - rescued axonal trafficking phenotypes without signs of TDP43 mislocalization or aggregation formation. Our data indicate TDP43 mutation-dependent but cytosolic aggregation-independent mechanisms of motor neuron degeneration in TDP43 ALS. |
|
Geurtzen K, Vernet A, Freidin A, Rauner M, Hofbauer LC, Schneider JE, Brand M, Knopf F
|
Immune Suppressive and Bone Inhibitory Effects of Prednisolone in Growing and Regenerating Zebrafish Tissues.
|
J Bone Miner Res. 2017 Dec;32(12):2476-2488
|
|
Medical Biology
|

|
28771888 |
ANIMAL MODELS; CORTICOSTEROIDS; OSTEOBLAST; OSTEOCLAST; OSTEOPOROSIS |
Glucocorticoids are widely used as therapeutic agents to treat immune-mediated diseases in humans because of their anti-inflammatory and immunosuppressive effects. However, glucocorticoids have various adverse effects, in particular rapid and pronounced bone loss associated with fractures in glucocorticoid-induced osteoporosis, a common form of secondary osteoporosis. In zebrafish, which are increasingly used to study processes of bone regeneration and disease, glucocorticoids show detrimental effects on bone tissue; however, the underlying cellular mechanisms are incompletely understood. Here, we show that treatment with the glucocorticoid prednisolone impacts on the number, activity and differentiation of osteoblasts, osteoclasts, and immune cells during ontogenetic growth, homeostasis, and regeneration of zebrafish bone. Macrophage numbers are reduced in both larval and adult tissues, correlating with decreased generation of myelomonocytes and enhanced apoptosis of these cells. In contrast, osteoblasts fail to proliferate, show decreased activity, and undergo incomplete differentiation. In addition, prednisolone treatment mitigates the number and recruitment of osteoclasts to sites of bone regeneration in adult fish. In combination, these effects delay bone growth and impair bone regeneration. Our study demonstrates the many-faceted effects of glucocorticoids in non-mammalian vertebrates and helps to further establish the zebrafish as a model to study glucocorticoid-induced osteoporosis. |
|
Lukas Wehmeier, Thomas Kämpfe, Alexander Haußmann, Lukas M. Eng
|
In Situ 3D Observation of the Domain Wall Dynamics in a Triglycine Sulfate Single Crystal upon Ferroelectric Phase Transition
|
Phys. Status Solidi RRL 2017, 11, 1700267
|
|
Physics
|

|
|
ferroelectrics, 3D imaging, non-linear optics, phase transitions, second-harmonic generation microscopy |
We present the first in situ 3D observation of domain wall dynamics close to a ferroelectric–paraelectric phase transition, which we obtain via second‐harmonic generation microscopy (SHGM). Showing a pure second‐order phase transition at its Curie temperature of 49 °C, triglycine sulfate (TGS) is a model ferroelectric material to study such phase transitions. After annealing, in TGS various qualitatively different domain patterns, e.g., stripes or small lenticular domains, have been reported so far. By applying SHGM, we can show that these findings do not necessarily contradict each other. In fact, qualitatively different domain patterns may coexist in the same TGS sample at the same time. |
|
Reinhardt L, Kordes S, Reinhardt P, Glatza M, Baumann M, Drexler HCA, Menninger S, Zischinsky G, Eickhoff J, Fröb C, Bhattarai P, Arulmozhivarman G, Marrone L, Janosch A, Adachi K, Stehling M, Anderson EN, Abo-Rady M, Bickle M, Pandey UB, Reimer MM, Kizil C, Schöler HR, Nussbaumer P, Klebl B, Sterneckert JL
|
Dual Inhibition of GSK3β and CDK5 Protects the Cytoskeleton of Neurons from Neuroinflammatory-Mediated Degeneration In Vitro and In Vivo.
|
Stem Cell Reports. 2019 Mar 5;12(3):502-517
|
|
Neurobiology
|
|
30773488 |
ALS; CDK5; GSK3β; induced pluripotent stem cells; neurodegeneration; neuroinflammation; stem cell-based phenotypic screening |
Neuroinflammation is a hallmark of neurological disorders and is accompanied by the production of neurotoxic agents such as nitric oxide. We used stem cell-based phenotypic screening and identified small molecules that directly protected neurons from neuroinflammation-induced degeneration. We demonstrate that inhibition of CDK5 is involved in, but not sufficient for, neuroprotection. Instead, additional inhibition of GSK3β is required to enhance the neuroprotective effects of CDK5 inhibition, which was confirmed using short hairpin RNA-mediated knockdown of CDK5 and GSK3β. Quantitative phosphoproteomics and high-content imaging demonstrate that neurite degeneration is mediated by aberrant phosphorylation of multiple microtubule-associated proteins. Finally, we show that our hit compound protects neurons in vivo in zebrafish models of motor neuron degeneration and Alzheimer's disease. Thus, we demonstrate an overlap of CDK5 and GSK3β in mediating the regulation of the neuronal cytoskeleton and that our hit compound LDC8 represents a promising starting point for neuroprotective drugs. |
|
Bragado Alonso S, Reinert JK, Marichal N, Massalini S, Berninger B, Kuner T, Calegari F
|
An increase in neural stem cells and olfactory bulb adult neurogenesis improves discrimination of highly similar odorants.
|
EMBO J. 2019 Mar 15;38(6)
|
- LMF CMCB
- EMF & Histo CMCB
- LMF DZNE
|
Neurobiology
|

|
30643018 |
adult neurogenesis; neural stem cells; odor discrimination |
Adult neurogenesis is involved in cognitive performance but studies that manipulated this process to improve brain function are scarce. Here, we characterized a genetic mouse model in which neural stem cells (NSC) of the subventricular zone (SVZ) were temporarily expanded by conditional expression of the cell cycle regulators Cdk4/cyclinD1, thus increasing neurogenesis. We found that supernumerary neurons matured and integrated in the olfactory bulb similarly to physiologically generated newborn neurons displaying a correct expression of molecular markers, morphology and electrophysiological activity. Olfactory performance upon increased neurogenesis was unchanged when mice were tested on relatively easy tasks using distinct odor stimuli. In contrast, intriguingly, increasing neurogenesis improved the discrimination ability of mice when challenged with a difficult task using mixtures of highly similar odorants. Together, our study provides a mammalian model to control the expansion of somatic stem cells that can in principle be applied to any tissue for basic research and models of therapy. By applying this to NSC of the SVZ, we highlighted the importance of adult neurogenesis to specifically improve performance in a challenging olfactory task. |
|
Thamm K, Šimaitė D, Karbanová J, Bermúdez V, Reichert D, Morgenstern A, Bornhäuser M, Huttner WB, Wilsch-Bräuninger M, Corbeil D
|
Prominin-1 (CD133) modulates the architecture and dynamics of microvilli.
|
Traffic. 2019 Jan;20(1):39-60
|
- LMF CMCB
- EMF & Histo CMCB
- EMF MPI-CBG
|
Cell Biology
|
|
30328220 |
Arp2/3 complex; CD133; epithelial cells; membrane vesicles; microvilli; phosphoinositide 3-kinase; prominin-1 |
Prominin-1 is a cell surface biomarker that allows the identification of stem and cancer stem cells from different organs. It is also expressed in several differentiated epithelial and non-epithelial cells. Irrespective of the cell type, prominin-1 is associated with plasma membrane protrusions. Here, we investigate its impact on the architecture of membrane protrusions using microvilli of Madin-Darby canine kidney cells as the main model. Our high-resolution analysis revealed that upon the overexpression of prominin-1 the number of microvilli and clusters of them increased. Microvilli with branched and/or knob-like morphologies were observed and stimulated by mutations in the ganglioside-binding site of prominin-1. The altered phenotypes were caused by the interaction of prominin-1 with phosphoinositide 3-kinase and Arp2/3 complex. Mutation of tyrosine 828 of prominin-1 impaired its phosphorylation and thereby inhibited the aforementioned interactions abolishing altered microvilli. This suggests that the interplay of prominin-1-ganglioside membrane complexes, phosphoinositide 3-kinase and cytoskeleton components regulates microvillar architecture. Lastly, the expression of prominin-1 and its mutants modified the structure of filopodia emerging from fibroblast-like cells and silencing human prominin-1 in primary hematopoietic stem cells resulted in the loss of uropod-associated microvilli. Altogether, these findings strengthen the role of prominin-1 as an organizer of cellular protrusions. |
|
Franz Kapplusch, Felix Schulzea, Sabrina Rabe-Matschewsky, Susanne Russa, Maik Herbig, Michael Christian Heymann, Katharina Schoepf, Robert Stein, Ursula Range, Angela Rösen-Wolff, Stefan Winkler, Christian Michael Hedrich, JochenGuck, Sigrun Ruth Hofmann
|
CASP1 variants influence subcellular caspase-1 localization, pyroptosome formation, pro-inflammatory cell death and macrophage deformability.
|
Clin Immunol. 2019 Nov;208:108232
|
|
Medical Biology
|
|
31252176 |
Apoptosis-associated speck-like protein containing a CARD (ASC); Caspase-1; Gasdermin D; IL-1β; Inflammasome; Interleukin-1 converting enzyme; NLRP3; Pyroptosis; Pyroptosome; Speck |
CASP1 variants result in reduced enzymatic activity of procaspase-1 and impaired IL-1β release. Despite this, affected individuals can develop systemic autoinflammatory disease. These seemingly contradictory observations have only partially been explained by increased NF-κB activation through prolonged interaction of variant procaspase-1 with RIP2. To identify further disease underlying pathomechanisms, we established an in vitro model using shRNA-directed knock-down of procaspase-1 followed by viral transduction of human monocytes (THP-1) with plasmids encoding for wild-type procaspase-1, disease-associated CASP1 variants (p.L265S, p.R240Q) or a missense mutation in the active center of procaspase-1 (p.C285A). THP1-derived macrophages carrying CASP1 variants exhibited mutation-specific molecular alterations. We here provide in vitro evidence for abnormal pyroptosome formation (p.C285A, p.240Q, p.L265S), impaired nuclear (pro)caspase-1 localization (p.L265S), reduced pro-inflammatory cell death (p.C285A) and changes in macrophage deformability that may contribute to disease pathophysiology of patients with CASP1 variants. This offers previously unknown molecular pathomechanisms in patients with systemic autoinflammatory disease. |
|
Marrone L, Drexler HCA, Wang J, Tripathi P, Distler T, Heisterkamp P, Anderson EN, Kour S, Moraiti A, Maharana S, Bhatnagar R, Belgard TG, Tripathy V, Kalmbach N, Hosseinzadeh Z, Crippa V, Abo-Rady M, Wegner F, Poletti A, Troost D, Aronica E, Busskamp V, Weis J, Pandey UB, Hyman AA, Alberti S, Goswami A, Sterneckert J
|
FUS pathology in ALS is linked to alterations in multiple ALS-associated proteins and rescued by drugs stimulating autophagy.
|
Acta Neuropathol. 2019 Jul;138(1):67-84
|
|
Medical Biology
|

|
30937520 |
Amyotrophic lateral sclerosis; FUS; Induced pluripotent stem cells; Phase transition; Protein homeostasis; RNA-binding proteins |
Amyotrophic lateral sclerosis (ALS) is a lethal disease characterized by motor neuron degeneration and associated with aggregation of nuclear RNA-binding proteins (RBPs), including FUS. How FUS aggregation and neurodegeneration are prevented in healthy motor neurons remain critically unanswered questions. Here, we use a combination of ALS patient autopsy tissue and induced pluripotent stem cell-derived neurons to study the effects of FUS mutations on RBP homeostasis. We show that FUS' tendency to aggregate is normally buffered by interacting RBPs, but this buffering is lost when FUS mislocalizes to the cytoplasm due to ALS mutations. The presence of aggregation-prone FUS in the cytoplasm causes imbalances in RBP homeostasis that exacerbate neurodegeneration. However, enhancing autophagy using small molecules reduces cytoplasmic FUS, restores RBP homeostasis and rescues motor function in vivo. We conclude that disruption of RBP homeostasis plays a critical role in FUS-ALS and can be treated by stimulating autophagy. |
|
Münster S, Jain A, Mietke A, Pavlopoulos A, Grill SW, Tomancak P
|
Attachment of the blastoderm to the vitelline envelope affects gastrulation of insects.
|
Nature. 2019 Apr;568(7752):395-399
|
|
Cell Biology
|

|
30918398 |
|
During gastrulation, physical forces reshape the simple embryonic tissue to form the complex body plans of multicellular organisms1. These forces often cause large-scale asymmetric movements of the embryonic tissue2,3. In many embryos, the gastrulating tissue is surrounded by a rigid protective shell4. Although it is well-recognized that gastrulation movements depend on forces that are generated by tissue-intrinsic contractility5,6, it is not known whether interactions between the tissue and the protective shell provide additional forces that affect gastrulation. Here we show that a particular part of the blastoderm tissue of the red flour beetle (Tribolium castaneum) tightly adheres in a temporally coordinated manner to the vitelline envelope that surrounds the embryo. This attachment generates an additional force that counteracts tissue-intrinsic contractile forces to create asymmetric tissue movements. This localized attachment depends on an αPS2 integrin (inflated), and the knockdown of this integrin leads to a gastrulation phenotype that is consistent with complete loss of attachment. Furthermore, analysis of another integrin (the αPS3 integrin, scab) in the fruit fly (Drosophila melanogaster) suggests that gastrulation in this organism also relies on adhesion between the blastoderm and the vitelline envelope. Our findings reveal a conserved mechanism through which the spatiotemporal pattern of tissue adhesion to the vitelline envelope provides controllable, counteracting forces that shape gastrulation movements in insects. |
|
Camargo Ortega G, Falk S, Johansson PA, Peyre E, Broix L, Sahu SK, Hirst W, Schlichthaerle T, De Juan Romero C, Draganova K, Vinopal S, Chinnappa K, Gavranovic A, Karakaya T, Steininger T, Merl-Pham J, Feederle R, Shao W, Shi SH, Hauck SM, Jungmann R, Bradke F, Borrell V, Geerlof A, Reber S, Tiwari VK, Huttner WB, Wilsch-Bräuninger M, Nguyen L, Götz M
|
The centrosome protein AKNA regulates neurogenesis via microtubule organization.
|
Nature. 2019 Mar;567(7746):113-117
|
|
Neurobiology
|

|
30787442 |
|
The expansion of brain size is accompanied by a relative enlargement of the subventricular zone during development. Epithelial-like neural stem cells divide in the ventricular zone at the ventricles of the embryonic brain, self-renew and generate basal progenitors1 that delaminate and settle in the subventricular zone in enlarged brain regions2. The length of time that cells stay in the subventricular zone is essential for controlling further amplification and fate determination. Here we show that the interphase centrosome protein AKNA has a key role in this process. AKNA localizes at the subdistal appendages of the mother centriole in specific subtypes of neural stem cells, and in almost all basal progenitors. This protein is necessary and sufficient to organize centrosomal microtubules, and promote their nucleation and growth. These features of AKNA are important for mediating the delamination process in the formation of the subventricular zone. Moreover, AKNA regulates the exit from the subventricular zone, which reveals the pivotal role of centrosomal microtubule organization in enabling cells to both enter and remain in the subventricular zone. The epithelial-to-mesenchymal transition is also regulated by AKNA in other epithelial cells, demonstrating its general importance for the control of cell delamination. |
|
Kostic M, Paridaen JTML, Long KR, Kalebic N, Langen B, Grübling N, Wimberger P, Kawasaki H, Namba T, Huttner WB
|
YAP Activity Is Necessary and Sufficient for Basal Progenitor Abundance and Proliferation in the Developing Neocortex.
|
Cell Rep. 2019 Apr 23;27(4):1103-1118
|
|
Developmental Biology
|

|
31018127 |
Hippo signaling; SVZ; YAP activity; basal progenitors; neocortical evolution |
Neocortex expansion during mammalian evolution has been linked to an increase in proliferation of basal progenitors in the subventricular zone. Here, we explored a potential role of YAP, the major downstream effector of the Hippo pathway, in proliferation of basal progenitors. YAP expression and activity are high in ferret and human basal progenitors, which exhibit high proliferative capacity, but low in mouse basal progenitors, which lack such capacity. Conditional expression of a constitutively active YAP in mouse basal progenitors resulted in increased proliferation of basal progenitor and promoted production of upper-layer neurons. Pharmacological and genetic interference with YAP function in ferret and human developing neocortex resulted in decreased abundance of cycling basal progenitors. Together, our data indicate that YAP is necessary and sufficient to promote the proliferation of basal progenitors and suggest that increases in YAP levels and presumably activity contributed to the evolutionary expansion of the neocortex. |
|
Skouloudaki K, Papadopoulos DK, Tomancak P, Knust E
|
The apical protein Apnoia interacts with Crumbs to regulate tracheal growth and inflation.
|
PLoS Genet. 2019 Jan 15;15(1)
|
- LMF MPI-CBG
- EMF MPI-CBG
- IPF MPI-CBG
|
Cell Biology
|

|
30645584 |
|
Most organs of multicellular organisms are built from epithelial tubes. To exert their functions, tubes rely on apico-basal polarity, on junctions, which form a barrier to separate the inside from the outside, and on a proper lumen, required for gas or liquid transport. Here we identify apnoia (apn), a novel Drosophila gene required for tracheal tube elongation and lumen stability at larval stages. Larvae lacking Apn show abnormal tracheal inflation and twisted airway tubes, but no obvious defects in early steps of tracheal maturation. apn encodes a transmembrane protein, primarily expressed in the tracheae, which exerts its function by controlling the localization of Crumbs (Crb), an evolutionarily conserved apical determinant. Apn physically interacts with Crb to control its localization and maintenance at the apical membrane of developing airways. In apn mutant tracheal cells, Crb fails to localize apically and is trapped in retromer-positive vesicles. Consistent with the role of Crb in apical membrane growth, RNAi-mediated knockdown of Crb results in decreased apical surface growth of tracheal cells and impaired axial elongation of the dorsal trunk. We conclude that Apn is a novel regulator of tracheal tube expansion in larval tracheae, the function of which is mediated by Crb. |
|
Kujawski S, Sonawane M, Knust E
|
penner/lgl2 is required for the integrity of the photoreceptor layer in the zebrafish retina.
|
Biol Open. 2019 Apr 23;8(4)
|
|
Cell Biology
|

|
31015218 |
Adhesion; Apico-basal polarity; Lamination; Plexiform layer |
The vertebrate retina is a complex tissue built from multiple neuronal cell types, which develop from a pseudostratified neuroepithelium. These cells are arranged into a highly organized and stereotypic pattern formed by nuclear and plexiform layers. The process of lamination as well as the maturation and differentiation of photoreceptor cells rely on the establishment and maintenance of apico-basal cell polarity and formation of adhesive junctions. Defects in any of these processes can result in impaired vision and are causally related to a variety of human diseases leading to blindness. While the importance of apical polarity regulators in retinal stratification and disease is well established, little is known about the function of basal regulators in retinal development. Here, we analyzed the role of Lgl2, a basolateral polarity factor, in the zebrafish retina. Lgl2 is upregulated in photoreceptor cells and in the retinal pigment epithelium by 72 h post fertilization. In both cell types, Lgl2 is localized basolaterally. Loss of zygotic Lgl2 does not interfere with retinal lamination or photoreceptor cell polarity or maturation. However, knockdown of both maternal and zygotic Lgl2 leads to impaired cell adhesion. As a consequence, severe layering defects occur in the distal retina, manifested by a breakdown of the outer plexiform layer and the outer limiting membrane. These results define zebrafish Lgl2 as an important regulator of retinal lamination, which, given the high degree of evolutionary conservation, may be preserved in other vertebrates, including human. |
|
Hartenstein V, Yuan M, Younossi-Hartenstein A, Karandikar A, Bernardo-Garcia FJ, Sprecher S, Knust E
|
Serial electron microscopic reconstruction of the drosophila larval eye: Photoreceptors with a rudimentary rhabdomere of microvillar-like processes.
|
Dev Biol. 2019 Sep 1;453(1):56-67
|
|
Developmental Biology
|
|
31158364 |
Bolwig organ; Development; Drosophila; Larval photoreceptor; Rhabdomere; Serial electron microscopy; Ultrastructure |
Photoreceptor cells (PRCs) across the animal kingdom are characterized by a stacking of apical membranes to accommodate the high abundance of photopigment. In arthropods and many other invertebrate phyla PRC membrane stacks adopt the shape of densely packed microvilli that form a structure called rhabdomere. PRCs and surrounding accessory cells, including pigment cells and lens-forming cells, are grouped in stereotyped units, the ommatidia. In larvae of holometabolan insects, eyes (called stemmata) are reduced in terms of number and composition of ommatidia. The stemma of Drosophila (Bolwig organ) is reduced to a bilateral cluster of subepidermal PRCs, lacking all other cell types. In the present paper we have analyzed the development and fine structure of the Drosophila larval PRCs. Shortly after their appearance in the embryonic head ectoderm, PRC precursors delaminate and lose expression of apical markers of epithelial cells, including Crumbs and several centrosome-associated proteins. In the early first instar larva, PRCs show an expanded, irregularly shaped apical surface that is folded into multiple horizontal microvillar-like processes (MLPs). Apical PRC membranes and MLPs are covered with a layer of extracellular matrix. MLPs are predominantly aligned along an axis that extends ventro-anteriorly to dorso-posteriorly, but vary in length, diameter, and spacing. Individual MLPs present a "beaded" shape, with thick segments (0.2-0.3 μm diameter) alternating with thin segments (>0.1 μm). We show that loss of the glycoprotein Chaoptin, which is absolutely essential for rhabdomere formation in the adult PRCs, does not lead to severe abnormalities in larval PRCs. |
|
Amini R, Labudina AA, Norden C
|
Stochastic single cell migration leads to robust horizontal cell layer formation in the vertebrate retina.
|
Development. 2019 May 24;146(12)
|
|
Developmental Biology
|

|
31126979 |
Horizontal cells; Migration and lamination; Retina; Stochastic single cell migration; Zebrafish |
Developmental programs that arrange cells and tissues into patterned organs are remarkably robust. In the developing vertebrate retina, for example, neurons reproducibly assemble into distinct layers giving the mature organ its overall structured appearance. This stereotypic neuronal arrangement, termed lamination, is important for efficient neuronal connectivity. Although retinal lamination is conserved in many vertebrates, including humans, how it emerges from single cell behaviour is not fully understood. To shed light on this issue, we here investigated the formation of the retinal horizontal cell layer. Using in vivo light sheet imaging of the developing zebrafish retina, we generated a comprehensive quantitative analysis of horizontal single cell behaviour from birth to final positioning. Interestingly, we find that all parameters analysed, including cell cycle dynamics, migration paths and kinetics, as well as sister cell dispersal, are very heterogeneous. Thus, horizontal cells show individual non-stereotypic behaviour before final positioning. Yet these initially variable cell dynamics always generate the correct laminar pattern. Consequently, our data show that the extent of single cell stochasticity in the lamination of the vertebrate retina is underexplored. |
|
Marini G, Pigino G
|
Yeast membraneless compartments revealed by correlative light microscopy and electron tomography.
|
Methods Cell Biol. 2019;152:103-117
|
|
Cell Biology
|

|
31326017 |
CLEM; Electron tomography; Membraneless compartments; Yeast essential enzymes; eIF2B Video S1 A tomogram of GFP-tagged eIF2B show elongated bundles of filaments that polymerize upon energy depletion |
Yeast essential enzymes are able to assemble and form membrane-less compartments in the cytoplasm during stress conditions (Narayanaswamy et al., 2009). These microcompartments form rapidly under ATP-depletion upon cellular regulation of pH and molecular crowding (Munder et al., 2016). So far, the behavior of most of these enzymes has been characterized by live imaging using fluorescence microscopy. The ultrastructure of only a few enzymes in the assembled form has been solved, thus revealing their capacity of forming highly ordered self-assemblies (Barry et al., 2014; Petrovska et al., 2014; Prouteau et al., 2017). Here we show how we used correlative light and electron microscopy (CLEM) and transmission electron tomography (ET) to reveal the in situ arrangement adopted by the yeast enzyme eIF2B (eukaryotic translation initiation 2B) in its compartmentalized form upon energy depletion. |
|
Jordan MA, Pigino G
|
In situ cryo-electron tomography and subtomogram averaging of intraflagellar transport trains.
|
Methods Cell Biol. 2019;152:179-195
|
|
Cell Biology
|

|
31326020 |
Cilia; Cryo-Tomography; Dynein; Intraflagellar transport; Motors; Subtomogram averaging |
In situ cryo-electron tomography (cryo-ET) and subtomogram averaging are powerful tools, able to provide 3D structures of biological samples at sub-nanometer resolution, while preserving information about cellular context and higher-order assembly. Best results are typically achieved, when applied to highly repetitive structures, such as viruses. Other typical examples are protein complexes that decorate long stretches along ciliary microtubules at stereotypical and precise repeats, such as axonemal dyneins. For such cases, a plethora of subtomogram averaging protocols exist. In this chapter, we show how we use cryo-ET and subtomogram averaging to study the architecture of the intraflagellar transport (IFT) machinery, a more challenging target that appears only in low copy numbers per tomogram. In the IFT trains, repeating units of IFT adaptor proteins engage two oppositely directed molecular motors to quickly shuttle ciliary building blocks and other proteins to the tip of the cilium and/or back to the base. This dynamic and sporadic nature of IFT trains poses challenges for determining the localization or precise orientation of the particles to be averaged. Solutions to these problems are described in this chapter. |
|
Thommen A, Werner S, Frank O, Philipp J, Knittelfelder O, Quek Y, Fahmy K, Shevchenko A, Friedrich BM, Jülicher F, Rink JC
|
Body size-dependent energy storage causes Kleiber's law scaling of the metabolic rate in planarians.
|
Elife. 2019 Jan 4;8
|
|
Developmental Biology
|

|
30608231 |
3/4-power law; Kleiber's law; energy metabolism; metabolic rate; metabolic scaling; physics of living systems; planaria; planarian |
Kleiber's law, or the 3/4 -power law scaling of the metabolic rate with body mass, is considered one of the few quantitative laws in biology, yet its physiological basis remains unknown. Here, we report Kleiber's law scaling in the planarian Schmidtea mediterranea. Its reversible and life history-independent changes in adult body mass over 3 orders of magnitude reveal that Kleiber's law does not emerge from the size-dependent decrease in cellular metabolic rate, but from a size-dependent increase in mass per cell. Through a combination of experiment and theoretical analysis of the organismal energy balance, we further show that the mass allometry is caused by body size dependent energy storage. Our results reveal the physiological origins of Kleiber's law in planarians and have general implications for understanding a fundamental scaling law in biology. |
|
Goto-Silva L, McShane MP, Salinas S, Kalaidzidis Y, Schiavo G, Zerial M
|
Retrograde transport of Akt by a neuronal Rab5-APPL1 endosome.
|
Sci Rep. 2019 Feb 21;9(1):2433
|
|
Cell Biology
|

|
30792402 |
|
Long-distance axonal trafficking plays a critical role in neuronal function and transport defects have been linked to neurodegenerative disorders. Various lines of evidence suggest that the small GTPase Rab5 plays a role in neuronal signaling via early endosomal transport. Here, we characterized the motility of Rab5 endosomes in primary cultures of mouse hippocampal pyramidal cells by live-cell imaging and showed that they exhibit bi-directional long-range motility in axons, with a strong bias toward retrograde transport. Characterization of key Rab5 effectors revealed that endogenous Rabankyrin-5, Rabenosyn-5 and APPL1 are all present in axons. Further analysis of APPL1-positive endosomes showed that, similar to Rab5-endosomes, they display more frequent long-range retrograde than anterograde movement, with the endosomal levels of APPL1 correlated with faster retrograde movement. Interestingly, APPL1-endosomes transport the neurotrophin receptor TrkB and mediate retrograde axonal transport of the kinase Akt1. FRET analysis revealed that APPL1 and Akt1 interact in an endocytosis-dependent manner. We conclude that Rab5-APPL1 endosomes exhibit the hallmarks of axonal signaling endosomes to transport Akt1 in hippocampal pyramidal cells. |
|
Morales-Navarrete H, Nonaka H, Scholich A, Segovia-Miranda F, de Back W, Meyer K, Bogorad RL, Koteliansky V, Brusch L, Kalaidzidis Y, Jülicher F, Friedrich BM, Zerial M
|
Liquid-crystal organization of liver tissue.
|
Elife. 2019 Jun 17;8
|
|
Biophysics
|

|
31204997 |
3D tissue organization; cell polarity; liquid crystal order; liver; mouse; physics of living systems |
Functional tissue architecture originates by self-assembly of distinct cell types, following tissue-specific rules of cell-cell interactions. In the liver, a structural model of the lobule was pioneered by Elias in 1949. This model, however, is in contrast with the apparent random 3D arrangement of hepatocytes. Since then, no significant progress has been made to derive the organizing principles of liver tissue. To solve this outstanding problem, we computationally reconstructed 3D tissue geometry from microscopy images of mouse liver tissue and analyzed it applying soft-condensed-matter-physics concepts. Surprisingly, analysis of the spatial organization of cell polarity revealed that hepatocytes are not randomly oriented but follow a long-range liquid-crystal order. This does not depend exclusively on hepatocytes receiving instructive signals by endothelial cells, since silencing Integrin-β1 disrupted both liquid-crystal order and organization of the sinusoidal network. Our results suggest that bi-directional communication between hepatocytes and sinusoids underlies the self-organization of liver tissue. |
|
Franke C, Repnik U, Segeletz S, Brouilly N, Kalaidzidis Y, Verbavatz JM, Zerial M
|
Correlative single-molecule localization microscopy and electron tomography reveals endosome nanoscale domains.
|
Traffic. 2019 Aug;20(8):601-617
|
|
Imaging Technologies Development
|

|
31206952 |
Rab5; Tokuyasu cryosectioning; electron tomography; electron-microscopy; endosomes; multicolor CLEM; single-molecule localization microscopy; super-resolution microscopy |
Many cellular organelles, including endosomes, show compartmentalization into distinct functional domains, which, however, cannot be resolved by diffraction-limited light microscopy. Single molecule localization microscopy (SMLM) offers nanoscale resolution but data interpretation is often inconclusive when the ultrastructural context is missing. Correlative light electron microscopy (CLEM) combining SMLM with electron microscopy (EM) enables correlation of functional subdomains of organelles in relation to their underlying ultrastructure at nanometer resolution. However, the specific demands for EM sample preparation and the requirements for fluorescent single-molecule photo-switching are opposed. Here, we developed a novel superCLEM workflow that combines triple-color SMLM (dSTORM & PALM) and electron tomography using semi-thin Tokuyasu thawed cryosections. We applied the superCLEM approach to directly visualize nanoscale compartmentalization of endosomes in HeLa cells. Internalized, fluorescently labeled Transferrin and EGF were resolved into morphologically distinct domains within the same endosome. We found that the small GTPase Rab5 is organized in nanodomains on the globular part of early endosomes. The simultaneous visualization of several proteins in functionally distinct endosomal sub-compartments demonstrates the potential of superCLEM to link the ultrastructure of organelles with their molecular organization at nanoscale resolution. |
|
Currie JD, Grosser L, Murawala P, Schuez M, Michel M, Tanaka EM, Sandoval-Guzmán T
|
The Prrx1 limb enhancer marks an adult subpopulation of injury-responsive dermal fibroblasts.
|
Biol Open. 2019 Jul 18;8(7)
|
|
Cell Biology
|

|
31278164 |
Dermal fibroblast; Limb progenitor; Lineage tracing; Wound healing |
The heterogeneous properties of dermal cell populations have been posited to contribute toward fibrotic, imperfect wound healing in mammals. Here we characterize an adult population of dermal fibroblasts that maintain an active Prrx1 enhancer which originally marked mesenchymal limb progenitors. In contrast to their abundance in limb development, postnatal Prrx1 enhancer-positive cells (Prrx1enh+) make up a small subset of adult dermal cells (∼0.2%) and reside mainly within dermal perivascular and hair follicle niches. Lineage tracing of adult Prrx1enh+ cells shows that they remain in their niches and in small numbers over a long period of time. Upon injury however, Prrx1enh+ cells readily migrate into the wound bed and amplify, on average, 16-fold beyond their uninjured numbers. Additionally, following wounding dermal Prrx1enh+ cells are found out of their dermal niches and contribute to subcutaneous tissue. Postnatal Prrx1enh+ cells are uniquely injury-responsive despite being a meager minority in the adult skin. |
|
Tondera C, Akbar TF, Thomas AK, Lin W, Werner C, Busskamp V, Zhang Y, Minev IR
|
Highly Conductive, Stretchable, and Cell-Adhesive Hydrogel by Nanoclay Doping.
|
Small. 2019 Jul;15(27):e1901406
|
|
Biomaterials
|

|
31025545 |
3D printing; bioelectronics; conductive polymers; induced pluripotent stem cells; interpenetrating network |
Electrically conductive materials that mimic physical and biological properties of tissues are urgently required for seamless brain-machine interfaces. Here, a multinetwork hydrogel combining electrical conductivity of 26 S m-1 , stretchability of 800%, and tissue-like elastic modulus of 15 kPa with mimicry of the extracellular matrix is reported. Engineering this unique set of properties is enabled by a novel in-scaffold polymerization approach. Colloidal hydrogels of the nanoclay Laponite are employed as supports for the assembly of secondary polymer networks. Laponite dramatically increases the conductivity of in-scaffold polymerized poly(ethylene-3,4-diethoxy thiophene) in the absence of other dopants, while preserving excellent stretchability. The scaffold is coated with a layer containing adhesive peptide and polysaccharide dextran sulfate supporting the attachment, proliferation, and neuronal differentiation of human induced pluripotent stem cells directly on the surface of conductive hydrogels. Due to its compatibility with simple extrusion printing, this material promises to enable tissue-mimetic neurostimulating electrodes. |
|
Pons-Espinal M, Gasperini C, Marzi MJ, Braccia C, Armirotti A, Pötzsch A, Walker TL, Fabel K, Nicassio F, Kempermann G, De Pietri Tonelli D
|
MiR-135a-5p Is Critical for Exercise-Induced Adult Neurogenesis.
|
Stem Cell Reports. 2019 Jun 11;12(6):1298-1312
|
|
Neurobiology
|

|
31130358 |
INPP4A; ITPR1; adult neurogenesis; aging; inositol 1,4,5-trisphosphate (IP3) pathway; miR-135a; running |
Physical exercise stimulates adult hippocampal neurogenesis and is considered a relevant strategy for preventing age-related cognitive decline in humans. The underlying mechanisms remains controversial. Here, we show that exercise increases proliferation of neural precursor cells (NPCs) of the mouse dentate gyrus (DG) via downregulation of microRNA 135a-5p (miR-135a). MiR-135a inhibition stimulates NPC proliferation leading to increased neurogenesis, but not astrogliogenesis, in DG of resting mice, and intriguingly it re-activates NPC proliferation in aged mice. We identify 17 proteins (11 putative targets) modulated by miR-135 in NPCs. Of note, inositol 1,4,5-trisphosphate (IP3) receptor 1 and inositol polyphosphate-4-phosphatase type I are among the modulated proteins, suggesting that IP3 signaling may act downstream miR-135. miR-135 is the first noncoding RNA essential modulator of the brain's response to physical exercise. Prospectively, the miR-135-IP3 axis might represent a novel target of therapeutic intervention to prevent pathological brain aging. |
|
Delgadillo-Silva LF, Tsakmaki A, Akhtar N, Franklin ZJ, Konantz J, Bewick GA, Ninov N
|
Modelling pancreatic β-cell inflammation in zebrafish identifies the natural product wedelolactone for human islet protection.
|
Dis Model Mech. 2019 Jan 23;12(1)
|
|
Medical Biology
|

|
30679186 |
Beta-cells; Diabetes; Inflammation; Insulin; Islet; Regeneration; Zebrafish |
Islet inflammation and cytokine production are implicated in pancreatic β-cell dysfunction and diabetes pathogenesis. However, we lack therapeutics to protect the insulin-producing β-cells from inflammatory damage. Closing this clinical gap requires the establishment of new disease models of islet inflammation to facilitate screening efforts aimed at identifying new protective agents. Here, we have developed a genetic model of Interleukin-1β (Il-1β)-driven islet inflammation in zebrafish, a vertebrate that allows for non-invasive imaging of β-cells and in vivo drug discovery. Live imaging of immune cells and β-cells in our model revealed dynamic migration, increased visitation and prolonged macrophage retention in the islet, together with robust activation of NF-κB signalling in β-cells. We find that Il-1β-mediated inflammation does not cause β-cell destruction but, rather, it impairs β-cell function and identity. In vivo, β-cells exhibit impaired glucose-stimulated calcium influx and reduced expression of genes involved in function and maturity. These defects are accompanied by α-cell expansion, glucose intolerance and hyperglycemia following a glucose challenge. Notably, we show that a medicinal plant derivative (wedelolactone) is capable of reducing the immune-cell infiltration while also ameliorating the hyperglycemic phenotype of our model. Importantly, these anti-diabetic properties in zebrafish are predictive of wedelolactone's efficacy in protecting rodent and human islets from cytokine-induced apoptosis. In summary, this new zebrafish model of diabetes opens a window to study the interactions between immune and β-cells in vivo, while also allowing the identification of therapeutic agents for protecting β-cells from inflammation. |
|
Poser SW, Otto O, Arps-Forker C, Ge Y, Herbig M, Andree C, Gruetzmann K, Adasme MF, Stodolak S, Nikolakopoulou P, Park DM, Mcintyre A, Lesche M, Dahl A, Lennig P, Bornstein SR, Schroeck E, Klink B, Leker RR, Bickle M, Chrousos GP, Schroeder M, Cannistraci CV, Guck J, Androutsellis-Theotokis A
|
Controlling distinct signaling states in cultured cancer cells provides a new platform for drug discovery.
|
FASEB J. 2019 Aug;33(8):9235-9249
|
|
Medical Biology
|

|
31145643 |
brain tumor; drug repurposing; glioblastoma; glioma; signal transduction |
Cancer cells can switch between signaling pathways to regulate growth under different conditions. In the tumor microenvironment, this likely helps them evade therapies that target specific pathways. We must identify all possible states and utilize them in drug screening programs. One such state is characterized by expression of the transcription factor Hairy and Enhancer of Split 3 (HES3) and sensitivity to HES3 knockdown, and it can be modeled in vitro. Here, we cultured 3 primary human brain cancer cell lines under 3 different culture conditions that maintain low, medium, and high HES3 expression and characterized gene regulation and mechanical phenotype in these states. We assessed gene expression regulation following HES3 knockdown in the HES3-high conditions. We then employed a commonly used human brain tumor cell line to screen Food and Drug Administration (FDA)-approved compounds that specifically target the HES3-high state. We report that cells from multiple patients behave similarly when placed under distinct culture conditions. We identified 37 FDA-approved compounds that specifically kill cancer cells in the high-HES3-expression conditions. Our work reveals a novel signaling state in cancer, biomarkers, a strategy to identify treatments against it, and a set of putative drugs for potential repurposing. |
|
Kapplusch F, Schulze F, Rabe-Matschewsky S, Russ S, Herbig M, Heymann MC, Schoepf K, Stein R, Range U, Rösen-Wolff A, Winkler S, Hedrich CM, Guck J, Hofmann SR
|
CASP1 variants influence subcellular caspase-1 localization, pyroptosome formation, pro-inflammatory cell death and macrophage deformability.
|
Clin Immunol. 2019 Nov;208:108232
|
|
Medical Biology
|
|
31252176 |
Apoptosis-associated speck-like protein containing a CARD (ASC); Caspase-1; Gasdermin D; IL-1β; Inflammasome; Interleukin-1 converting enzyme; NLRP3; Pyroptosis; Pyroptosome; Speck |
CASP1 variants result in reduced enzymatic activity of procaspase-1 and impaired IL-1β release. Despite this, affected individuals can develop systemic autoinflammatory disease. These seemingly contradictory observations have only partially been explained by increased NF-κB activation through prolonged interaction of variant procaspase-1 with RIP2. To identify further disease underlying pathomechanisms, we established an in vitro model using shRNA-directed knock-down of procaspase-1 followed by viral transduction of human monocytes (THP-1) with plasmids encoding for wild-type procaspase-1, disease-associated CASP1 variants (p.L265S, p.R240Q) or a missense mutation in the active center of procaspase-1 (p.C285A). THP1-derived macrophages carrying CASP1 variants exhibited mutation-specific molecular alterations. We here provide in vitro evidence for abnormal pyroptosome formation (p.C285A, p.240Q, p.L265S), impaired nuclear (pro)caspase-1 localization (p.L265S), reduced pro-inflammatory cell death (p.C285A) and changes in macrophage deformability that may contribute to disease pathophysiology of patients with CASP1 variants. This offers previously unknown molecular pathomechanisms in patients with systemic autoinflammatory disease. |
|
Görlich S, Pawolski D, Zlotnikov I, Kröger N
|
Control of biosilica morphology and mechanical performance by the conserved diatom gene Silicanin-1.
|
Commun Biol. 2019 Jun 28;2:245
|
- EMF & Histo CMCB
- MIM Facility CMCB
|
Biomaterials
|

|
31286062 |
Biomineralization; Cell wall; Mutagenesis |
The species-specifically patterned biosilica cell walls of diatoms are paradigms for biological mineral morphogenesis and the evolution of lightweight materials with exceptional mechanical performance. Biosilica formation is a membrane-mediated process that occurs in intracellular compartments, termed silica deposition vesicles (SDVs). Silicanin-1 (Sin1) is a highly conserved protein of the SDV membrane, but its role in biosilica formation has remained elusive. Here we generate Sin1 knockout mutants of the diatom Thalassiosira pseudonana. Although the mutants grow normally, they exhibit reduced biosilica content and morphological aberrations, which drastically compromise the strength and stiffness of their cell walls. These results identify Sin1 as essential for the biogenesis of mechanically robust diatom cell walls, thus providing an explanation for the conservation of this gene throughout the diatom realm. This insight paves the way for genetic engineering of silica architectures with desired structures and mechanical performance. |
|
Haustein N, Gutiérrez-Sanz Ó, Tarasov A
|
Analytical Model To Describe the Effect of Polyethylene Glycol on Ionic Screening of Analyte Charges in Transistor-Based Immunosensing.
|
ACS Sens. 2019 Apr 26;4(4):874-882
|
|
Applied Chemistry
|

|
30839200 |
Debye screening length; Donnan potential; competitive binding; field-effect transistor; immunosensing |
Recently, the co-immobilization of polyethylene glycol has improved sensor responses of transistor-based immunosensing by approximately three times. However, there is currently no analytical model available to explain this empirical effect. The key parameters thought to affect the potential are the receptor density, the capacitance, the analyte charge, and the dissociation constant. Based on our experimental data, only the analyte charge can account for the signal enhancement. To capture the effect of PEG on the analyte charge, we introduce a prefactor, the detectable charge qdet, which represents the portion of analyte charges effectively detected by the sensor. This parameter can quantitatively describe the PEG-induced signal enhancement and can be used to recommend the choice of PEG size for immuno-field-effect transistors. Additionally, we include the competition between electrolyte ions and the analyte for binding to the recognition molecule to more accurately describe the concentration-dependent sensor responses than the traditional Langmuir binding model does. |
|
Bellmann J, Monette A, Tripathy V, Sójka A, Abo-Rady M, Janosh A, Bhatnagar R, Bickle M, Mouland AJ, Sterneckert J
|
Viral Infections Exacerbate FUS-ALS Phenotypes in iPSC-Derived Spinal Neurons in a Virus Species-Specific Manner.
|
Front Cell Neurosci. 2019 Oct 22;13:480
|
|
Medical Biology
|

|
31695598 |
FUS; HIV-1; Zika virus; amyotrophic lateral sclerosis; induced pluripotent stem cells; rabies virus |
Amyotrophic lateral sclerosis (ALS) arises from an interplay of genetic mutations and environmental factors. ssRNA viruses are possible ALS risk factors, but testing their interaction with mutations such as in FUS, which encodes an RNA-binding protein, has been difficult due to the lack of a human disease model. Here, we use isogenic induced pluripotent stem cell (iPSC)-derived spinal neurons (SNs) to investigate the interaction between ssRNA viruses and mutant FUS. We find that rabies virus (RABV) spreads ALS phenotypes, including the formation of stress granules (SGs) with aberrant composition due to increased levels of FUS protein, as well as neurodegeneration and reduced restriction activity by FUS mutations. Consistent with this, iPSC-derived SNs harboring mutant FUS are more sensitive to human immunodeficiency virus (HIV-1) and Zika viruses (ZIKV). We demonstrate that RABV and HIV-1 exacerbate cytoplasmic mislocalization of FUS. Our results demonstrate that viral infections worsen ALS pathology in SNs with genetic risk factors, suggesting a novel role for viruses in modulating patient phenotypes. |
|
Bellmann J, Goswami RY, Girardo S, Rein N, Hosseinzadeh Z, Hicks MR, Busskamp V, Pyle AD, Werner C, Sterneckert J
|
A customizable microfluidic platform for medium-throughput modeling of neuromuscular circuits.
|
Biomaterials. 2019 Dec;225:119537
|
|
Biomaterials
|

|
31614290 |
Microfluidics; Motor unit; Neuromuscular circuit; Rabies viral tracing; Skeletal muscle; poly(ethylene-alt-maleic anhydride) |
Neuromuscular circuits (NMCs) are vital for voluntary movement, and effective models of NMCs are needed to understand the pathogenesis of, as well as to identify effective treatments for, multiple diseases, including Duchenne's muscular dystrophy and amyotrophic lateral sclerosis. Microfluidics are ideal for recapitulating the central and peripheral compartments of NMCs, but myotubes often detach before functional NMCs are formed. In addition, microfluidic systems are often limited to a single experimental unit, which significantly limits their application in disease modeling and drug discovery. Here, we developed a microfluidic platform (MFP) containing over 100 experimental units, making it suitable for medium-throughput applications. To overcome detachment, we incorporated a reactive polymer surface allowing customization of the environment to culture different cell types. Using this approach, we identified conditions that enable long-term co-culture of human motor neurons and myotubes differentiated from human induced pluripotent stem cells inside our MFP. Optogenetics demonstrated the formation of functional NMCs. Furthermore, we developed a novel application of the rabies tracing assay to efficiently identify NMCs in our MFP. Therefore, our MFP enables large-scale generation and quantification of functional NMCs for disease modeling and pharmacological drug targeting. |
|
Kessel F, Steglich A, Tschongov T, Gembardt F, Ruhnke L, Stumpf J, Behrendt R, Cohrs C, Kopaliani I, Todorov V, Gerlach M, Hugo C
|
New automatic quantification method of immunofluorescence and histochemistry in whole histological sections.
|
Cell Signal. 2019 Oct;62:109335
|
|
Image Processing
|

|
31170471 |
Automatic quantification; Cell count; Histochemistry; Immunofluorescence; Morphology |
Immunofluorescent staining is a widespread tool in basic science to understand organ morphology and (patho-) physiology. The analysis of imaging data is often performed manually, limiting throughput and introducing human bias. Quantitative analysis is particularly challenging for organs with complex structure such as the kidney. In this study we present an approach for automatic quantification of fluorescent markers and histochemical stainings in whole organ sections using open source software. We validate our novel method in multiple typical challenges of basic kidney research and demonstrate its general relevance and applicability to other complex solid organs for a variety of different markers and stainings. Our newly developed software tool "AQUISTO", applied as a standard in primary data analysis, facilitates efficient large scale evaluation of cellular populations in various types of histological samples. Thereby it contributes to the characterization and understanding of (patho-) physiological processes. |
|
Mediani L, Guillén-Boixet J, Vinet J, Franzmann TM, Bigi I, Mateju D, Carrà AD, Morelli FF, Tiago T, Poser I, Alberti S, Carra S
|
Defective ribosomal products challenge nuclear function by impairing nuclear condensate dynamics and immobilizing ubiquitin.
|
EMBO J. 2019 Aug 1;38(15)
|
|
Cell Biology
|

|
31271238 |
defective ribosomal products; membraneless organelles; molecular chaperones; nucleus; proteostasis |
Nuclear protein aggregation has been linked to genome instability and disease. The main source of aggregation-prone proteins in cells is defective ribosomal products (DRiPs), which are generated by translating ribosomes in the cytoplasm. Here, we report that DRiPs rapidly diffuse into the nucleus and accumulate in nucleoli and PML bodies, two membraneless organelles formed by liquid-liquid phase separation. We show that nucleoli and PML bodies act as dynamic overflow compartments that recruit protein quality control factors and store DRiPs for later clearance. Whereas nucleoli serve as constitutive overflow compartments, PML bodies are stress-inducible overflow compartments for DRiPs. If DRiPs are not properly cleared by chaperones and proteasomes due to proteostasis impairment, nucleoli undergo amyloidogenesis and PML bodies solidify. Solid PML bodies immobilize 20S proteasomes and limit the recycling of free ubiquitin. Ubiquitin depletion, in turn, compromises the formation of DNA repair compartments at fragile chromosomal sites, ultimately threatening cell survival. |
|
Baumgart J, Kirchner M, Redemann S, Bond A, Woodruff J, Verbavatz JM, Jülicher F, Müller-Reichert T, Hyman AA, Brugués J
|
Soluble tubulin is significantly enriched at mitotic centrosomes.
|
J Cell Biol. 2019 Dec 2;218(12):3977-3985
|
|
Cell Biology
|

|
31636117 |
|
During mitosis, the centrosome expands its capacity to nucleate microtubules. Understanding the mechanisms of centrosomal microtubule nucleation is, however, constrained by a lack of knowledge of the amount of soluble and polymeric tubulin at mitotic centrosomes. Here we combined light microscopy and serial-section electron tomography to measure the amount of dimeric and polymeric tubulin at mitotic centrosomes in early C. elegans embryos. We show that a C. elegans one-cell stage centrosome at metaphase contains >10,000 microtubules with a total polymer concentration of 230 µM. Centrosomes concentrate soluble α/β tubulin by about 10-fold over the cytoplasm, reaching peak values of 470 µM, giving a combined total monomer and polymer tubulin concentration at centrosomes of up to 660 µM. These findings support in vitro data suggesting that microtubule nucleation in C. elegans centrosomes is driven in part by concentrating soluble tubulin. |
|
Bajur AT, Iyer KV, Knust E
|
Cytocortex-dependent dynamics of Drosophila Crumbs controls junctional stability and tension during germ band retraction.
|
J Cell Sci. 2019 Aug 7;132(15)
|
|
Cell Biology
|

|
31300472 |
Apical; FERM protein; FRAP; Moesin; Morphogenesis; βH-spectrin |
During morphogenesis, epithelia undergo dynamic rearrangements, which requires continuous remodelling of junctions and cell shape, but at the same time mechanisms preserving cell polarity and tissue integrity. Apico-basal polarity is key for the localisation of the machinery that enables cell shape changes. The evolutionarily conserved Drosophila Crumbs protein is critical for maintaining apico-basal polarity and epithelial integrity. How Crumbs is maintained in a dynamically developing embryo remains largely unknown. Here, we applied quantitative fluorescence techniques to show that, during germ band retraction, Crumbs dynamics correlates with the morphogenetic activity of the epithelium. Genetic and pharmacological perturbations revealed that the mobile pool of Crumbs is fine-tuned by the actomyosin cortex in a stage-dependent manner. Stabilisation of Crumbs at the plasma membrane depends on a proper link to the actomyosin cortex via an intact FERM-domain-binding site in its intracellular domain, loss of which leads to increased junctional tension and higher DE-cadherin (also known as Shotgun) turnover, resulting in impaired junctional rearrangements. These data define Crumbs as a mediator between polarity and junctional regulation to orchestrate epithelial remodelling in response to changes in actomyosin activity.This article has an associated First Person interview with the first author of the paper. |
|
Shull G, Haffner C, Huttner WB, Kodandaramaiah SB, Taverna E
|
Robotic platform for microinjection into single cells in brain tissue.
|
EMBO Rep. 2019 Oct 4;20(10):e47880
|
|
Neurobiology
|
|
31469223 |
brain development; computer vision; neural stem cells; robotics; single cell manipulation |
Microinjection into single cells in brain tissue is a powerful technique to study and manipulate neural stem cells. However, such microinjection requires expertise and is a low-throughput process. We developed the "Autoinjector", a robot that utilizes images from a microscope to guide a microinjection needle into tissue to deliver femtoliter volumes of liquids into single cells. The Autoinjector enables microinjection of hundreds of cells within a single organotypic slice, resulting in an overall yield that is an order of magnitude greater than manual microinjection. The Autoinjector successfully targets both apical progenitors (APs) and newborn neurons in the embryonic mouse and human fetal telencephalon. We used the Autoinjector to systematically study gap-junctional communication between neural progenitors in the embryonic mouse telencephalon and found that apical contact is a characteristic feature of the cells that are part of a gap junction-coupled cluster. The throughput and versatility of the Autoinjector will render microinjection an accessible high-performance single-cell manipulation technique and will provide a powerful new platform for performing single-cell analyses in tissue for bioengineering and biophysics applications. |
|
Lattner J, Leng W, Knust E, Brankatschk M, Flores-Benitez D
|
Crumbs organizes the transport machinery by regulating apical levels of PI(4,5)P2 in Drosophila.
|
Elife. 2019 Nov 7;8. pii: e50900
|
|
Cell Biology
|

|
31697234 |
D. melanogaster; cell biology; cell polarity; epithelial cells; live imaging |
An efficient vectorial intracellular transport machinery depends on a well-established apico-basal polarity and is a prerequisite for the function of secretory epithelia. Despite extensive knowledge on individual trafficking pathways, little is known about the mechanisms coordinating their temporal and spatial regulation. Here, we report that the polarity protein Crumbs is essential for apical plasma membrane phospholipid-homeostasis and efficient apical secretion. Through recruiting βHeavy-Spectrin and MyosinV to the apical membrane, Crumbs maintains the Rab6-, Rab11- and Rab30-dependent trafficking and regulates the lipid phosphatases Pten and Ocrl. Crumbs knock-down results in increased apical levels of PI(4,5)P2 and formation of a novel, Moesin- and PI(4,5)P2-enriched apical membrane sac containing microvilli-like structures. Our results identify Crumbs as an essential hub required to maintain the organization of the apical membrane and the physiological activity of the larval salivary gland. |
|
Wagner N, Schuhmacher M, Lohmann A, Nadler A
|
A Coumarin Triflate Reagent Enables One-Step Synthesis of Photo-Caged Lipid Metabolites for Studying Cell Signaling.
|
Chemistry. 2019 Dec 5;25(68):15483-15487
|
|
Applied Chemistry
|

|
31461184 |
caged compounds; cell signaling; lipids; one-step synthesis; platelet activating factor |
Photorelease of caged compounds is among the most powerful experimental approaches for studying cellular functions on fast timescales. However, its full potential has yet to be exploited, as the number of caged small molecules available for cell biological studies has been limited by synthetic challenges. Addressing this problem, a straightforward, one-step procedure for efficiently synthesizing caged compounds was developed. An in situ generated benzylic coumarin triflate reagent was used to specifically functionalize carboxylate and phosphate moieties in the presence of free hydroxy groups, generating various caged lipid metabolites, including a number of GPCR ligands. By combining the photo-caged ligands with the respective receptors, an easily implementable experimental platform for the optical control and analysis of GPCR-mediated signal transduction in living cells was developed. Ultimately, the described synthetic strategy allows rapid generation of photo-caged small molecules and thus greatly facilitates the analysis of their biological roles in live cell microscopy assays. |
|
Yanakieva I, Erzberger A, Matejčić M, Modes CD, Norden C
|
Cell and tissue morphology determine actin-dependent nuclear migration mechanisms in neuroepithelia.
|
J Cell Biol. 2019 Oct 7;218(10):3272-3289
|
|
Cell Biology
|

|
31420451 |
|
Correct nuclear position is crucial for cellular function and tissue development. Depending on cell context, however, the cytoskeletal elements responsible for nuclear positioning vary. While these cytoskeletal mechanisms have been intensely studied in single cells, how nuclear positioning is linked to tissue morphology is less clear. Here, we compare apical nuclear positioning in zebrafish neuroepithelia. We find that kinetics and actin-dependent mechanisms of nuclear positioning vary in tissues of different morphology. In straight neuroepithelia, nuclear positioning is controlled by Rho-ROCK-dependent myosin contractility. In contrast, in basally constricted neuroepithelia, a novel formin-dependent pushing mechanism is found for which we propose a proof-of-principle force generation theory. Overall, our data suggest that correct nuclear positioning is ensured by the adaptability of the cytoskeleton to cell and tissue shape. This in turn leads to robust epithelial maturation across geometries. The conclusion that different nuclear positioning mechanisms are favored in tissues of different morphology highlights the importance of developmental context for the execution of intracellular processes. |
|
Pinto CS, Khandekar A, Bhavna R, Kiesel P, Pigino G, Sonawane M
|
Microridges are apical epithelial projections formed of F-actin networks that organize the glycan layer.
|
Sci Rep. 2019 Aug 21;9(1):12191
|
|
Cell Biology
|
|
31434932 |
|
Apical projections are integral functional units of epithelial cells. Microvilli and stereocilia are cylindrical apical projections that are formed of bundled actin. Microridges on the other hand, extend laterally, forming labyrinthine patterns on surfaces of various kinds of squamous epithelial cells. So far, the structural organization and functions of microridges have remained elusive. We have analyzed microridges on zebrafish epidermal cells using confocal and electron microscopy methods including electron tomography, to show that microridges are formed of F-actin networks and require the function of the Arp2/3 complex for their maintenance. During development, microridges begin as F-actin punctae showing signatures of branching and requiring an active Arp2/3 complex. Using inhibitors of actin polymerization and the Arp2/3 complex, we show that microridges organize the surface glycan layer. Our analyses have unraveled the F-actin organization supporting the most abundant and evolutionarily conserved apical projection, which functions in glycan organization. |
|
Skouloudaki K, Christodoulou I, Khalili D, Tsarouhas V, Samakovlis C, Tomancak P, Knust E, Papadopoulos DK
|
Yorkie controls tube length and apical barrier integrity during airway development.
|
J Cell Biol. 2019 Aug 5;218(8):2762-2781
|
|
Cell Biology
|

|
31315941 |
|
Epithelial organ size and shape depend on cell shape changes, cell-matrix communication, and apical membrane growth. The Drosophila melanogaster embryonic tracheal network is an excellent model to study these processes. Here, we show that the transcriptional coactivator of the Hippo pathway, Yorkie (YAP/TAZ in vertebrates), plays distinct roles in the developing Drosophila airways. Yorkie exerts a cytoplasmic function by binding Drosophila Twinstar, the orthologue of the vertebrate actin-severing protein Cofilin, to regulate F-actin levels and apical cell membrane size, which are required for proper tracheal tube elongation. Second, Yorkie controls water tightness of tracheal tubes by transcriptional regulation of the δ-aminolevulinate synthase gene (Alas). We conclude that Yorkie has a dual role in tracheal development to ensure proper tracheal growth and functionality. |
|
Lauer J, Segeletz S, Cezanne A, Guaitoli G, Raimondi F, Gentzel M, Alva V, Habeck M, Kalaidzidis Y, Ueffing M, Lupas AN, Gloeckner CJ, Zerial M
|
Auto-regulation of Rab5 GEF activity in Rabex5 by allosteric structural changes, catalytic core dynamics and ubiquitin binding.
|
Elife. 2019 Nov 13;8. pii: e46302
|
|
Cell Biology
|

|
31718772 |
Rab5; guanine nucleotide exchange factor (GEF); hydrogen deuterium exchange mass spectrometry (HDX-MS); molecular biophysics; structural biology |
Intracellular trafficking depends on the function of Rab GTPases, whose activation is regulated by guanine exchange factors (GEFs). The Rab5 GEF, Rabex5, was previously proposed to be auto-inhibited by its C-terminus. Here, we studied full-length Rabex5 and Rabaptin5 proteins as well as domain deletion Rabex5 mutants using hydrogen deuterium exchange mass spectrometry. We generated a structural model of Rabex5, using chemical cross-linking mass spectrometry and integrative modeling techniques. By correlating structural changes with nucleotide exchange activity for each construct, we uncovered new auto-regulatory roles for the ubiquitin binding domains and the Linker connecting those domains to the catalytic core of Rabex5. We further provide evidence that enhanced dynamics in the catalytic core are linked to catalysis. Our results suggest a more complex auto-regulation mechanism than previously thought and imply that ubiquitin binding serves not only to position Rabex5 but to also control its Rab5 GEF activity through allosteric structural alterations. |
|
Träber N, Uhlmann K, Girardo S, Kesavan G, Wagner K, Friedrichs J, Goswami R, Bai K, Brand M, Werner C, Balzani D, Guck J
|
Polyacrylamide Bead Sensors for in vivo Quantification of Cell-Scale Stress in Zebrafish Development.
|
Sci Rep. 2019 Nov 19;9(1):17031
|
|
Biophysics
|

|
31745109 |
|
Mechanical stress exerted and experienced by cells during tissue morphogenesis and organ formation plays an important role in embryonic development. While techniques to quantify mechanical stresses in vitro are available, few methods exist for studying stresses in living organisms. Here, we describe and characterize cell-like polyacrylamide (PAAm) bead sensors with well-defined elastic properties and size for in vivo quantification of cell-scale stresses. The beads were injected into developing zebrafish embryos and their deformations were computationally analyzed to delineate spatio-temporal local acting stresses. With this computational analysis-based cell-scale stress sensing (COMPAX) we are able to detect pulsatile pressure propagation in the developing neural rod potentially originating from polarized midline cell divisions and continuous tissue flow. COMPAX is expected to provide novel spatio-temporal insight into developmental processes at the local tissue level and to facilitate quantitative investigation and a better understanding of morphogenetic processes. |
|
Schmidt JR, Geurtzen K, von Bergen M, Schubert K, Knopf F
|
Glucocorticoid Treatment Leads to Aberrant Ion and Macromolecular Transport in Regenerating Zebrafish Fins.
|
Front Endocrinol. 2019 Oct 4;10:674
|
|
Cell Biology
|

|
31636606 |
ATPase; fin regeneration; glucocorticoid; lysosome; proteome; zebrafish |
Long-term glucocorticoid administration in patients undergoing immunosuppressive and anti-inflammatory treatment is accompanied by impaired bone formation and increased fracture risk. Furthermore, glucocorticoid treatment can lead to impaired wound healing and altered cell metabolism. Recently, we showed that exposure of zebrafish to the glucocorticoid prednisolone during fin regeneration impacts negatively on the length, bone formation, and osteoblast function of the regenerate. The underlying cellular and molecular mechanisms of impairment, however, remain incompletely understood. In order to further elucidate the anti-regenerative effects of continued glucocorticoid exposure on fin tissues, we performed proteome profiling of fin regenerates undergoing prednisolone treatment, in addition to profiling of homeostatic fin tissue and fins undergoing undisturbed regeneration. By using LC-MS (liquid chromatography-mass spectrometry) we identified more than 6,000 proteins across all tissue samples. In agreement with previous reports, fin amputation induces changes in chromatin structure and extracellular matrix (ECM) composition within the tissue. Notably, prednisolone treatment leads to impaired expression of selected ECM components in the fin regenerate. Moreover, the function of ion transporting ATPases and other proteins involved in macromolecule and vesicular transport mechanisms of the cell appears to be altered by prednisolone treatment. In particular, acidification of membrane-enclosed organelles such as lysosomes is inhibited. Taken together, our data indicate that continued synthetic glucocorticoid exposure in zebrafish deteriorates cellular trafficking processes in the regenerating fin, which interferes with appropriate tissue restoration upon injury. |
|
Völkner M, Kurth T, Karl MO
|
he Mouse Retinal Organoid Trisection Recipe: Efficient Generation of 3D Retinal Tissue from Mouse Embryonic Stem Cells.
|
Methods Mol Biol. 2019;1834:119-141
|
|
Cell Biology
|
|
30324441 |
(Single) Organoid QPCR studies; AAV infection; Cell birth dating; Cone photoreceptors; DAPT; Electron microscopy; Immunohistochemistry; Mouse embryonic stem cell (mESC); Mouse retinal organoids (MRO); Photoreceptor-enriched organoids; RNA isolation |
The introduction of stem cell-based technologies for the derivation of three-dimensional retinal tissues, the so-called retinal organoids, offers many new possibilities for vision research: Organoids facilitate studies on retinal development and in vitro retinal disease modeling, as well as being valuable for drug testing. Further, retinal organoids also provide an unlimited cell source for cell replacement therapies. Here, we describe our protocol for efficiently differentiating large, stratified retinal organoids from mouse embryonic stem cells: unbiased manual dissection of the developing retinal organoid at an early stage into three evenly sized neuroepithelial portions (trisection step) doubles the yield of high-quality organoids. We also describe some useful applications of the protocol, e.g., generation of rod- or cone-enriched retinal organoids, AAV transfection, and cell birth dating. In addition, we provide details of how to process retinal organoids for single organoid gene expression analysis, immunohistochemistry, and electron microscopy. |
|
Schoeppler V, Lemanis R, Reich E, Pusztai T, Gránásy L, Zlotnikov I
|
Crystal growth kinetics as an architectural constraint on the evolution of molluscan shells.
|
Proc Natl Acad Sci U S A. 2019 Oct 8;116(41):20388-20397
|
|
Biomaterials
|

|
31551265 |
biomineralization; crystal growth; molluscs; morphogenesis; solidification |
Molluscan shells are a classic model system to study formation-structure-function relationships in biological materials and the process of biomineralized tissue morphogenesis. Typically, each shell consists of a number of highly mineralized ultrastructures, each characterized by a specific 3D mineral-organic architecture. Surprisingly, in some cases, despite the lack of a mutual biochemical toolkit for biomineralization or evidence of homology, shells from different independently evolved species contain similar ultrastructural motifs. In the present study, using a recently developed physical framework, which is based on an analogy to the process of directional solidification and simulated by phase-field modeling, we compare the process of ultrastructural morphogenesis of shells from 3 major molluscan classes: A bivalve Unio pictorum, a cephalopod Nautilus pompilius, and a gastropod Haliotis asinina We demonstrate that the fabrication of these tissues is guided by the organisms by regulating the chemical and physical boundary conditions that control the growth kinetics of the mineral phase. This biomineralization concept is postulated to act as an architectural constraint on the evolution of molluscan shells by defining a morphospace of possible shell ultrastructures that is bounded by the thermodynamics and kinetics of crystal growth. |
|
Xu Y, Cui M, Patsis PA, Günther M, Yang X, Eckert K, Zhang Y
|
Reversibly Assembled Electroconductive Hydrogel via a Host-Guest Interaction for 3D Cell Culture.
|
ACS Appl Mater Interfaces. 2019 Feb 27;11(8):7715-7724
|
|
Applied Chemistry
|

|
30714715 |
3D cell culture; PEDOT; electroconductive hydrogel; host−guest; self-assembly |
The study of cells responding to an electroconductive environment is impeded by the lack of a method, which would allow the encapsulation of cells in an extracellular matrix-like 3D electroactive matrix, and more challengingly, permit a simple mechanism to release cells for further characterization. Herein, we report a polysaccharide-based conductive hydrogel system formed via a β-cyclodextrin-adamantane host-guest interaction. Oxidative polymerization of 3,4-ethylenedioxythiophene (EDOT) in the presence of adamantyl-modified sulfated alginate (S-Alg-Ad) results in bio-electroconductive polymer PEDOT:S-Alg-Ad, which can form hydrogel with poly-β-cyclodextrin (Pβ-CD). The PEDOT:S-Alg-Ad/Pβ-CD hydrogels can be tuned on aspects of mechanical and electrical properties, exhibit self-healing feature, and are injectable. Electron microscopy suggested that the difference in stiffness and conductivity is associated with the nacre-like layered nanostructures when different sizes of PEDOT:S-Alg-Ad nanoparticles were used. Myoblast C2C12 cells were encapsulated in the conductive hydrogel and exhibited proliferation rate comparable to that in nonconductive S-Alg-Ad/Pβ-CD hydrogel. The cells could be released from the hydrogels by adding the β-CD monomer. Astonishingly, the conductive hydrogel can dramatically promote myotube-like structure formation, which is not in the non-electroconductive hydrogel. The ability to embed and release cells in an electroconductive environment will open new doors for cell culture and tissue engineering. |
|
Papadopoulos DK, Skouloudaki K, Engström Y, Terenius L, Rigler R, Zechner C, Vukojević V, Tomancak P
|
Control of Hox transcription factor concentration and cell-to-cell variability by an auto-regulatory switch.
|
Development. 2019 Jan 25;146(12)
|
|
Biophysics
|

|
30642837 |
Auto-regulation; Fluorescence correlation spectroscopy; Hox genes; Protein noise; Transcription factors; Variability |
The variability in transcription factor concentration among cells is an important developmental determinant, yet how variability is controlled remains poorly understood. Studies of variability have focused predominantly on monitoring mRNA production noise. Little information exists about transcription factor protein variability, as this requires the use of quantitative methods with single-molecule sensitivity. Using Fluorescence Correlation Spectroscopy (FCS), we have characterized the concentration and variability of 14 endogenously tagged TFs in live Drosophila imaginal discs. For the Hox TF Antennapedia, we investigated whether protein variability results from random stochastic events or is developmentally regulated. We found that Antennapedia transitioned from low concentration/high variability early, to high concentration/low variability later, in development. FCS and temporally resolved genetic studies uncovered that Antennapedia itself is necessary and sufficient to drive a developmental regulatory switch from auto-activation to auto-repression, thereby reducing variability. This switch is controlled by progressive changes in relative concentrations of preferentially activating and repressing Antennapedia isoforms, which bind chromatin with different affinities. Mathematical modeling demonstrated that the experimentally supported auto-regulatory circuit can explain the increase of Antennapedia concentration and suppression of variability over time. |
|
Xu Y, Patsis PA, Hauser S, Voigt D, Rothe R, Günther M, Cui M, Yang X, Wieduwild R, Eckert K, Neinhuis C, Akbar TF, Minev IR, Pietzsch J, Zhang Y
|
Cytocompatible, Injectable, and Electroconductive Soft Adhesives with Hybrid Covalent/Noncovalent Dynamic Network.
|
Adv Sci (Weinh). 2019 May 24;6(15):1802077
|
|
Biomaterials
|

|
31406658 |
3D cell culture; PEDOT; adhesion; biocompatibility; small animal magnetic resonance imaging |
Synthetic conductive biopolymers have gained increasing interest in tissue engineering, as they can provide a chemically defined electroconductive and biomimetic microenvironment for cells. In addition to low cytotoxicity and high biocompatibility, injectability and adhesiveness are important for many biomedical applications but have proven to be very challenging. Recent results show that fascinating material properties can be realized with a bioinspired hybrid network, especially through the synergy between irreversible covalent crosslinking and reversible noncovalent self-assembly. Herein, a polysaccharide-based conductive hydrogel crosslinked through noncovalent and reversible covalent reactions is reported. The hybrid material exhibits rheological properties associated with dynamic networks such as self-healing and stress relaxation. Moreover, through fine-tuning the network dynamics by varying covalent/noncovalent crosslinking content and incorporating electroconductive polymers, the resulting materials exhibit electroconductivity and reliable adhesive strength, at a similar range to that of clinically used fibrin glue. The conductive soft adhesives exhibit high cytocompatibility in 2D/3D cell cultures and can promote myogenic differentiation of myoblast cells. The heparin-containing electroconductive adhesive shows high biocompatibility in immunocompetent mice, both for topical application and as injectable materials. The materials could have utilities in many biomedical applications, especially in the area of cardiovascular diseases and wound dressing. |
|
Viktorinová I, Haase R, Pietzsch T, Henry I, Tomancak P
|
Analysis of Actomyosin Dynamics at Local Cellular and Tissue Scales Using Time-lapse Movies of Cultured Drosophila Egg Chambers.
|
J Vis Exp. 2019 Jun 3;(148)
|
|
Image Processing
|
|
31205315 |
|
Drosophila immature eggs are called egg chambers, and their structure resembles primitive organs that undergo morphological changes from a round to an ellipsoid shape during development. This developmental process is called oogenesis and is crucial to generating functional mature eggs to secure the next fly generation. For these reasons, egg chambers have served as an ideal and relevant model to understand animal organ development. Several in vitro culturing protocols have been developed, but there are several disadvantages to these protocols. One involves the application of various covers that exert an artificial pressure on the imaged egg chambers in order to immobilize them and to increase the imaged acquisition plane of the circumferential surface of the analyzed egg chambers. Such an approach may negatively influence the behavior of the thin actomyosin machinery that generates the power to rotate egg chambers around their longer axis. Thus, to overcome this limitation, we culture Drosophila egg chambers freely in the media in order to reliably analyze actomyosin machinery along the circumference of egg chambers. In the first part of the protocol, we provide a manual detailing how to analyze the actomyosin machinery in a limited acquisition plane at the local cellular scale (up to 15 cells). In the second part of the protocol, we provide users with a new Fiji-based plugin that allows the simple extraction of a defined thin layer of the egg chambers' circumferential surface. The following protocol then describes how to analyze actomyosin signals at the tissue scale (>50 cells). Finally, we pinpoint the limitations of these approaches at both the local cellular and tissue scales and discuss its potential future development and possible applications. |
|
Celikkaya H, Cosacak MI, Papadimitriou C, Popova S, Bhattarai P, Biswas SN, Siddiqui T, Wistorf S, Nevado-Alcalde I, Naumann L, Mashkaryan V, Brandt K, Freudenberg U, Werner C, Kizil C
|
GATA3 Promotes the Neural Progenitor State but Not Neurogenesis in 3D Traumatic Injury Model of Primary Human Cortical Astrocytes.
|
Front Cell Neurosci. 2019 Feb 11;13:23
|
|
Neurobiology
|

|
30809125 |
GATA3; SOX2; neural progenitors; neurogenic potential; primary human astrocytes; scratch injury |
Astrocytes are abundant cell types in the vertebrate central nervous system and can act as neural stem cells in specialized niches where they constitutively generate new neurons. Outside the stem cell niches, however, these glial cells are not neurogenic. Although injuries in the mammalian central nervous system lead to profound proliferation of astrocytes, which cluster at the lesion site to form a gliotic scar, neurogenesis does not take place. Therefore, a plausible regenerative therapeutic option is to coax the endogenous reactive astrocytes to a pre-neurogenic progenitor state and use them as an endogenous reservoir for repair. However, little is known on the mechanisms that promote the neural progenitor state after injuries in humans. Gata3 was previously found to be a mechanism that zebrafish brain uses to injury-dependent induction of neural progenitors. However, the effects of GATA3 in human astrocytes after injury are not known. Therefore, in this report, we investigated how overexpression of GATA3 in primary human astrocytes would affect the neurogenic potential before and after injury in 2D and 3D cultures. We found that primary human astrocytes are unable to induce GATA3 after injury. Lentivirus-mediated overexpression of GATA3 significantly increased the number of GFAP/SOX2 double positive astrocytes and expression of pro-neural factor ASCL1, but failed to induce neurogenesis, suggesting that GATA3 is required for enhancing the neurogenic potential of primary human astrocytes and is not sufficient to induce neurogenesis alone. |
|
Cosacak MI, Bhattarai P, Reinhardt S, Petzold A, Dahl A, Zhang Y, Kizil C
|
Single-Cell Transcriptomics Analyses of Neural Stem Cell Heterogeneity and Contextual Plasticity in a Zebrafish Brain Model of Amyloid Toxicity.
|
Cell Rep. 2019 Apr 23;27(4):1307-1318
|
|
Neurobiology
|

|
31018142 |
Alzheimer’s disease; Fgf signaling; amyloid-beta42; interaction map; interleukin-4; neural stem cell; neuron; plasticity; single cell sequencing; zebrafish |
The neural stem cell (NSC) reservoir can be harnessed for stem cell-based regenerative therapies. Zebrafish remarkably regenerate their brain by inducing NSC plasticity in a Amyloid-β-42 (Aβ42)-induced experimental Alzheimer's disease (AD) model. Interleukin-4 (IL-4) is also critical for AD-induced NSC proliferation. However, the mechanisms of this response have remained unknown. Using single-cell transcriptomics in the adult zebrafish brain, we identify distinct subtypes of NSCs and neurons and differentially regulated pathways and their gene ontologies and investigate how cell-cell communication is altered through ligand-receptor pairs in AD conditions. Our results propose the existence of heterogeneous and spatially organized stem cell populations that react distinctly to amyloid toxicity. This resource article provides an extensive database for the molecular basis of NSC plasticity in the AD model of the adult zebrafish brain. Further analyses of stem cell heterogeneity and neuro-regenerative ability at single-cell resolution could yield drug targets for mobilizing NSCs for endogenous neuro-regeneration in humans. |
|
Victoria Salem, Luis Delgadillo Silva, Kinga Suba, Eleni Georgiadou, S. Neda Mousavy Gharavy, Nadeem Akhtar, Aldara Martin-Alonso, David C. A. Gaboriau, Stephen M. Rothery, Theodoros Stylianides, Gaelle Carrat, Timothy J. Pullen, Sumeet Pal Singh, David J. Hodson, Isabelle Leclerc, A. M. James Shapiro, Piero Marchetti, Linford J. B. Briant, Walter Distaso, Nikolay Ninov & Guy A. Rutter
|
Leader β-cells coordinate Ca2+ dynamics across pancreatic islets in vivo
|
Nat Metab 1, 615–629 (2019)
|
|
Medical Biology
|

|
|
|
Pancreatic β-cells form highly connected networks within isolated islets. Whether this behaviour pertains to the situation in vivo, after innervation and during continuous perfusion with blood, is unclear. In the present study, we used the recombinant Ca2+ sensor GCaMP6 to assess glucose-regulated connectivity in living zebrafish Danio rerio, and in murine or human islets transplanted into the anterior eye chamber. In each setting, Ca2+ waves emanated from temporally defined leader β-cells, and three-dimensional connectivity across the islet increased with glucose stimulation. Photoablation of zebrafish leader cells disrupted pan-islet signalling, identifying these as likely pacemakers. Correspondingly, in engrafted mouse islets, connectivity was sustained during prolonged glucose exposure, and super-connected ‘hub’ cells were identified. Granger causality analysis revealed a controlling role for temporally defined leaders, and transcriptomic analyses revealed a discrete hub cell fingerprint. We thus define a population of regulatory β-cells within coordinated islet networks in vivo. This population may drive Ca2+ dynamics and pulsatile insulin secretion. |
|
Gross P, Kumar KV, Goehring NW, Bois JS, Hoege C, Jülicher F, Grill SW
|
Guiding self-organized pattern formation in cell polarity establishment.
|
Nat Phys. 2019 Jul 2;15(3):293-300
|
|
Biophysics
|

|
31327978 |
|
Spontaneous pattern formation in Turing systems relies on feedback. Patterns in cells and tissues however often do not form spontaneously, but are under control of upstream pathways that provide molecular guiding cues. The relationship between guiding cues and feedback in controlled biological pattern formation remains unclear. We explored this relationship during cell polarity establishment in the one-cell-stage C. elegans embryo. We quantified the strength of two feedback systems that operate during polarity establishment, feedback between polarity proteins and the actomyosin cortex, and mutual antagonism amongst polarity proteins. We characterized how these feedback systems are modulated by guiding cues from the centrosome. By coupling a mass-conserved Turing-like reaction-diffusion system for polarity proteins to an active gel description of the actomyosin cortex, we reveal a transition point beyond which feedback ensures self-organized polarization even when cues are removed. Notably, the baton is passed from a guide-dominated to a feedback-dominated regime significantly beyond this transition point, which ensures robustness. Together, this reveals a general criterion for controlling biological pattern forming systems: feedback remains subcritical to avoid unstable behaviour, and molecular guiding cues drive the system beyond a transition point for pattern formation. |
|
Giannios I, Serafimidis I, Anastasiou V, Pezzolla D, Lesche M, Andree C, Bickle M, Gavalas A
|
Protein Methyltransferase Inhibition Decreases Endocrine Specification Through the Upregulation of Aldh1b1 Expression.
|
Stem Cells. 2019 May;37(5):640-651
|
- LMF CMCB
- Screening MPI-CBG
|
Cell Biology
|

|
30681750 |
Aldehyde dehydrogenase 1b1; Embryonic stem cell pancreas differentiation; Endocrine specification; Pancreas development; Pancreatic progenitors; β-Cells |
Understanding the mechanisms that promote the specification of pancreas progenitors and regulate their self-renewal and differentiation will help to maintain and expand pancreas progenitor cells derived from human pluripotent stem (hPS) cells. This will improve the efficiency of current differentiation protocols of hPS cells into β-cells and bring such cells closer to clinical applications for the therapy of diabetes. Aldehyde dehydrogenase 1b1 (Aldh1b1) is a mitochondrial enzyme expressed specifically in progenitor cells during mouse pancreas development, and we have shown that its functional inactivation leads to accelerated differentiation and deficient β-cells. In this report, we aimed to identify small molecule inducers of Aldh1b1 expression taking advantage of a mouse embryonic stem (mES) cell Aldh1b1 lacZ reporter line and a pancreas differentiation protocol directing mES cells into pancreatic progenitors. We identified AMI-5, a protein methyltransferase inhibitor, as an Aldh1b1 inducer and showed that it can maintain Aldh1b1 expression in embryonic pancreas explants. This led to a selective reduction in endocrine specification. This effect was due to a downregulation of Ngn3, and it was mediated through Aldh1b1 since the effect was abolished in Aldh1b1 null pancreata. The findings implicated methyltransferase activity in the regulation of endocrine differentiation and showed that methyltransferases can act through specific regulators during pancreas differentiation. |
|
Schreiber M, Weigelt M, Karasinsky A, Anastassiadis K, Schallenberg S, Petzold C, Bonifacio E, Kretschmer K, Hommel A
|
Inducible IL-7 Hyperexpression Influences Lymphocyte Homeostasis and Function and Increases Allograft Rejection.
|
Front Immunol. 2019 Apr 10;10:742
|
|
Medical Biology
|

|
31024566 |
Interleukin-7; Treg; allograft rejection; immunosuppression; islet transplantation |
The IL-7/IL-7R pathway is essential for lymphocyte development and disturbances in the pathway can lead to immune deficiency or T cell mediated destruction. Here, the effect of transient hyperexpression of IL-7 was investigated on immune regulation and allograft rejection under immunosuppression. An experimental in vivo immunosuppressive mouse model of IL-7 hyperexpression was developed using transgenic mice (C57BL/6 background) carrying a tetracycline inducible IL-7 expression cassette, which allowed the temporally controlled induction of IL-7 hyperexpression by Dexamethasone and Doxycycline treatment. Upon induction of IL-7, the B220+ c-kit+ Pro/Pre-B I compartment in the bone marrow increased as compared to control mice in a serum IL-7 concentration-correlated manner. IL-7 hyperexpression also preferentially increased the population size of memory CD8+ T cells in secondary lymphoid organs, and reduced the proportion of CD4+Foxp3+ T regulatory cells. Of relevance to disease, conventional CD4+ T cells from an IL-7-rich milieu escaped T regulatory cell-mediated suppression in vitro and in a model of autoimmune diabetes in vivo. These findings were validated using an IL-7/anti-IL7 complex treatment mouse model to create an IL-7 rich environment. To study the effect of IL-7 on islet graft survival in a mismatched allograft model, BALB/c mice were rendered diabetic by streptozotocin und transplanted with IL-7-inducible or control islets from C57BL/6 mice. As expected, Dexamethasone and Doxycycline treatment prolonged graft median survival as compared to the untreated control group in this transplantation mouse model. However, upon induction of local IL-7 hyperexpression in the transplanted islets, graft survival time was decreased and this was accompanied by an increased CD4+ and CD8+ T cell infiltration in the islets. Altogether, the findings show that transient elevations of IL-7 can impair immune regulation and lead to graft loss also under immune suppression. |
|
Santos MF, Rappa G, Karbanová J, Vanier C, Morimoto C, Corbeil D, Lorico A
|
Anti-human CD9 antibody Fab fragment impairs the internalization of extracellular vesicles and the nuclear transfer of their cargo proteins.
|
J Cell Mol Med. 2019 Jun;23(6):4408-4421
|
|
Medical Biology
|

|
30982221 |
CD9; Fab fragment; cancer; endocytosis; extracellular vesicle; nucleoplasm |
The intercellular communication mediated by extracellular vesicles (EVs) has gained international interest during the last decade. Interfering with the mechanisms regulating this cellular process might find application particularly in oncology where cancer cell-derived EVs play a role in tumour microenvironment transformation. Although several mechanisms were ascribed to explain the internalization of EVs, little is our knowledge about the fate of their cargos, which are crucial to mediate their function. We recently demonstrated a new intracellular pathway in which a fraction of endocytosed EV-associated proteins is transported into the nucleoplasm of the host cell via a subpopulation of late endosomes penetrating into the nucleoplasmic reticulum. Silencing tetraspanin CD9 both in EVs and recipient cells strongly decreased the endocytosis of EVs and abolished the nuclear transfer of their cargos. Here, we investigated whether monovalent Fab fragments derived from 5H9 anti-CD9 monoclonal antibody (referred hereafter as CD9 Fab) interfered with these cellular processes. To monitor the intracellular transport of proteins, we used fluorescent EVs containing CD9-green fluorescent protein fusion protein and various melanoma cell lines and bone marrow-derived mesenchymal stromal cells as recipient cells. Interestingly, CD9 Fab considerably reduced EV uptake and the nuclear transfer of their proteins in all examined cells. In contrast, the divalent CD9 antibody stimulated both events. By impeding intercellular communication in the tumour microenvironment, CD9 Fab-mediated inhibition of EV uptake, combined with direct targeting of cancerous cells could lead to the development of novel anti-melanoma therapeutic strategies. |
|
Rojo Arias JE, Economopoulou M, Juárez López DA, Kurzbach A, Au Yeung KH, Englmaier V, Merdausl M, Schaarschmidt M, Ader M, Morawietz H, Funk RHW, Jászai J
|
VEGF-Trap is a potent modulator of vasoregenerative responses and protects dopaminergic amacrine network integrity in degenerative ischemic neovascular retinopathy.
|
J Neurochem. 2019 Sep 24
|
|
Medical Biology
|

|
31550048 |
aflibercept; dopaminergic amacrine cells; endothelial tip cells; neovascularization; oxygen-induced retinopathy; vegf-trap |
Retinal hypoxia triggers abnormal vessel growth and microvascular hyper-permeability in ischemic retinopathies. Whereas vascular endothelial growth factor A (VEGF-A) inhibitors significantly hinder disease progression, their benefits to retinal neurons remain poorly understood. Similar to humans, oxygen-induced retinopathy (OIR) mice exhibit severe retinal microvascular malformations and profound neuronal dysfunction. OIR mice are thus a phenocopy of human retinopathy of prematurity, and a proxy for investigating advanced stages of proliferative diabetic retinopathy. Hence, the OIR model offers an excellent platform for assessing morpho-functional responses of the ischemic retina to anti-angiogenic therapies. Using this model, we investigated the retinal responses to VEGF-Trap (Aflibercept), an anti-angiogenic agent recognizing ligands of VEGF receptors 1 and 2 that possesses regulatory approval for the treatment of neovascular age-related macular degeneration, macular edema secondary to retinal vein occlusion and diabetic macular edema. Our results indicate that Aflibercept not only reduces the severity of retinal microvascular aberrations but also significantly improves neuroretinal function. Aflibercept administration significantly enhanced light-responsiveness, as revealed by electroretinographic examinations, and led to increased numbers of dopaminergic amacrine cells. Additionally, retinal transcriptional profiling revealed the concerted regulation of both angiogenic and neuronal targets, including transcripts encoding subunits of transmitter receptors relevant to amacrine cell function. Thus, Aflibercept represents a promising therapeutic alternative for the treatment of further progressive ischemic retinal neurovasculopathies beyond the set of disease conditions for which it has regulatory approval. |
|
Trautenberg LC, Prince E, Maas C, Beier N, Honold F, Grzybek M, Brankatschk M
|
Selective Phosphorylation of Akt/Protein-Kinase B Isoforms in Response to Dietary Cues.
|
Front Cell Dev Biol. 2019 Oct 10;7:206
|
|
Cell Biology
|

|
31649929 |
Akt; Akt phosphorylation; Cystobasidium oligophagum; Drosophila; PKB; Saccharomyces cerevisiae; insulin signaling; yeast lipids |
A calorie-rich diet is one reason for the continuous spread of metabolic syndromes in western societies. Smart food design is one powerful tool to prevent metabolic stress, and the search for suitable bioactive additives is a continuous task. The nutrient-sensing insulin pathway is an evolutionary conserved mechanism that plays an important role in metabolism, growth and development. Recently, lipid cues capable to stimulate insulin signaling were identified. However, the mechanistic base of their activity remains obscure to date. We show that specific Akt/Protein-kinase B isoforms are responsive to different calorie-rich diets, and potentiate the activity of the cellular insulin cascade. Our data add a new dimension to existing models and position Drosophila as a powerful tool to study the relation between dietary lipid cues and the insulin-induced cellular signal pathway. |
|
Ahlfeld T, Schuster FP, Förster Y, Quade M, Akkineni AR, Rentsch C, Rammelt S, Gelinsky M, Lode A
|
3D Plotted Biphasic Bone Scaffolds for Growth Factor Delivery: Biological Characterization In Vitro and In Vivo.
|
Adv Healthc Mater. 2019 Apr;8(7)
|
|
Medical Biology
|

|
30838778 |
VEGF; bone formation; calcium phosphate cement; multichannel 3D plotting; osteogenic differentiation; vascularization |
Bioprinting enables the integration of biological components into scaffolds during fabrication that has the advantage of high loading efficiency and better control of release and/or spatial positioning. In this study, a biphasic scaffold fabricated by extrusion-based 3D multichannel plotting of a calcium phosphate cement (CPC) paste and an alginate/gellan gum (AlgGG) hydrogel paste laden with the angiogenic factor VEGF (vascular endothelial growth factor) is investigated with regard to biological response in vitro and in vivo. Rat mesenchymal stromal cells are able to adhere and grow on both CPC and AlgGG strands, and differentiate toward osteoblasts. A sustained VEGF release is observed, which is able to stimulate endothelial cell proliferation as well as angiogenesis in vitro that indicates maintenance of its biological activity. After implantation into a segmental bone defect in the femur diaphysis of rats, a clear reduction of the defect size by newly formed bone tissue occurs from the distal and proximal ends of the host bone within 12 weeks. The CPC component shows excellent osteoconductivity whereas the local VEGF release from the AlgGG hydrogel gives rise to an enhanced vascularization of the defect region. This work contributes to the development of novel therapeutic concepts for improved bone regeneration which are based on 3D bioprinting. |